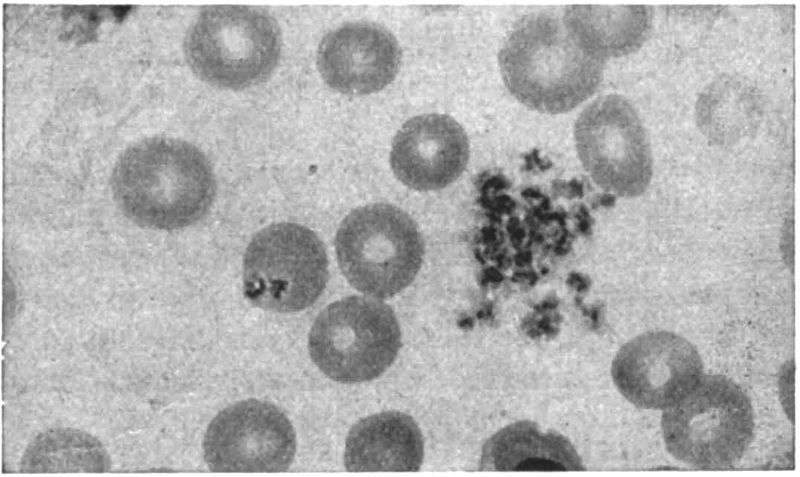

TRANSCRIBER’S NOTE
The cover image was created by the transcriber and is placed in the public domain.
Some minor changes to the text are noted at the end of the book.
THE DIAGNOSTICS
AND
TREATMENT OF TROPICAL DISEASES
BY
E. R. STITT, A. B., Ph. G., M. D., Sc. D., LL. D.
REAR ADMIRAL, MEDICAL CORPS, AND SURGEON GENERAL, U. S. NAVY, GRADUATE, LONDON
SCHOOL OF TROPICAL MEDICINE; MEMBER NATIONAL BOARD OF MEDICAL EXAMINERS; MEMBER
ADVISORY BOARD, HYGIENIC LABORATORY. FORMERLY: COMMANDING OFFICER AND HEAD
OF DEPARTMENT OF TROPICAL MEDICINE, U. S. NAVAL MEDICAL SCHOOL; PROFESSOR
OF TROPICAL MEDICINE, GEORGETOWN UNIVERSITY, PROFESSOR OF TROPICAL
MEDICINE, GEORGE WASHINGTON UNIVERSITY; LECTURER IN TROPICAL MEDICINE,
JEFFERSON MEDICAL COLLEGE; ASSOCIATE PROFESSOR OF MEDICAL
ZOOLOGY, UNIVERSITY OF THE PHILIPPINES
FOURTH EDITION—REVISED
WITH 159 ILLUSTRATIONS
LONDON
H. K. LEWIS AND CO., LTD.
1922
Copyright, 1922, by P. Blakiston’s Son & Co
PRINTED IN U. S. A.
BY THE MAPLE PRESS YORK PA
PREFACE TO FOURTH EDITION
In this revision it has seemed desirable to adhere to the original plan of the manual as such an arrangement of the contents gives to the student or tropical practitioner a concise and readily accessible presentation of the subject.
Accepting the spirochaetal etiology of yellow fever, as worked out by Noguchi, I have transferred the chapter on this disease to the section dealing with protozoal diseases and have endeavored to present the more important features of the recent extensive additions to our knowledge concerning this scourge of the tropics.
There is not a chapter in the book that has not been carefully revised and brought up to date. Of the revisions made, the most important deal with advances in the study of food deficiency diseases, as will be noted under beriberi and pellagra.
I have enlarged various paragraphs on treatment, the additions including descriptions of the treatment of hookworm disease by carbon tetrachloride and of the methods of administering arsphenamine and antimony.
Six new chapters have been added to the book, viz. Epidemic jaundice, rat bite fever, tularaemia, tables of helminthic and arthropodan diseases, trench fever, in Part I, and, in Part II, a chapter on the diagnostics of tropical joint, muscle and bone lesions.
Extensive additions have been made to Chapter XLIII, “Diagnostic problems and procedures, together with cosmopolitan diseases in the tropics”; and in the chapter on blood examinations will be found a presentation of our latest views as to acidosis as well as a table giving the significance of the findings in blood chemistry.
Many new illustrations have been added and some of the older ones replaced by others of greater teaching value.
Every effort has been made to retain the feature of a pocket manual but it has been necessary to increase the number of pages from 524 to 610. The illustrations in the third edition numbered 119; in this edition, 159.
In particular I have to express my indebtedness to Commanders C. S. Butler and H. W. Smith of the Naval Medical Corps for advice and assistance in the preparation of this edition. Dr. G. W. McCoy, Director of the Hygienic Laboratory, has given me valued suggestions as to changes in some of the old chapters and in the preparation of the new chapter on Tularaemia.
Lieutenant Commander Bunker, the head of the Chemical Laboratory of the Naval Medical School, has made the revisions of the subjects dealing with physiological chemistry. Others, who have given me advice and suggestions, have been Lieutenant Commander Reed and Lieutenants Harper and Chambers of the Naval Medical School.
To Lieutenant Peterson I am indebted for assistance in the proofreading and preparation of the index as well as in going over the recent literature of tropical diseases.
PREFACE TO FIRST EDITION
There is no more striking evidence of advance in general medicine than the present attitude of the physician or rather internist in the diagnosis of the cases met with in a modern hospital ward. Instead of first considering the evidence obtainable at the bedside and then noting the laboratory findings as something apart and entirely subordinate, we now find the two aids to diagnosis so correlated that it is as difficult to note one kind of information as bedside and other as laboratory as it formerly was to separate signs from symptoms in the study of a case.
In tropical medicine, however, we have for many years made our diagnosis in the laboratory, the bedside playing a subsidiary part—the laboratory diagnosis is controlled by the bedside findings.
It was originally my idea to prepare a book which would enable students to have presented to them in intimate relation the laboratory and clinical aids to the diagnosis of tropical diseases. I was forced to abandon this plan as it did not seem possible to take up clinical diagnosis prior to the obtaining by the student of a comprehensive knowledge of the facts in connection with each separate tropical disease. There was not the same difficulty attaching to a book exclusively devoted to the diagnostic methods of the laboratory so that in 1908 a laboratory manual was published. More recently it has occurred to me that my methods in teaching tropical medicine from the clinical rather than the laboratory standpoint might be of assistance to those who are interested in this very important branch of medicine.
When we consider that a knowledge of malaria, blackwater fever, amoebic dysentery, bacillary dysentery, liver abscess, pellagra and hookworm disease is just as important for the medical man in the Southern States of the United States as for the physician in tropical colonial possessions, it will be realized that there is more of a practical side to tropical medicine than is usually admitted.
Although this is intended as a companion volume to the one on laboratory methods yet, in order to make it complete in itself, there has been prepared under each disease a paragraph dealing with the laboratory diagnosis of the disease under consideration.
Furthermore, under the sections on the blood, faeces and urine in the diagnosis of tropical diseases, the laboratory methods which are of practical application have been given.
The chief feature of the book is in presenting in Part II the clinical side of tropical diseases from a standpoint of the signs and symptoms of these diseases which are connected with anatomical or clinical groupings rather than from the side of the individual disease. Thus in Chapter XLIV the diagnostic points which may be obtained from a study of the temperature chart are given while in Chapter LII the neurological manifestations, which may be noted in various tropical diseases, are presented.
In Part I each individual tropical disease is treated as taken up in any of the well-known books on tropical medicine. It has seemed to me, however, that the paragraphs on epidemiology and prophylaxis should receive especial attention. Again, in order to bring out more strongly the symptomatology of each disease, I have followed the paragraph on symptomatology in general with a section dealing with the symptoms in detail, as shown in a consideration of the circulatory, respiratory, digestive, nervous and other systems.
The paragraph devoted to the definition of each important disease has been prepared with a view to giving the reader a brief description of the disease in its clinical and etiological aspects.
Small type has been used rather to supply headings than for the purpose of indicating less important matter because in a book so condensed it has not seemed advisable to present any subject not of practical value.
This book is written from the standpoint of the teacher who aims not only to give the essential points but to present them in a manner so cross-referenced that the student has the subject presented to him from every angle.
It has been my custom in preparing my lectures to abstract the various works on tropical medicine in order that special points in one book, not noted in the others, would stand out prominently. In this connection I am deeply indebted to the manuals of Manson, Scheube, Castellani and Chalmers, LeDantec, Jeanselme and Rist as well as to the monographs in Maladies Exotiques, Albutt’s System of Medicine, Osler’s System of Medicine, Mense’s Tropenkrankheiten and Traite Pratique de Pathologie Exotique.
In particular I am indebted to Ruge and zurVerth’s Tropenkrankheiten,[ix] to Brumpt’s Precis de Parasitologie and to the only work in the diagnosis of tropical diseases I have been able to obtain, that of Wurtz and Thiroux, entitled Maladies Tropicales.
In the section on blood examination I have advocated the adoption of the scheme of differential counting brought out in Schilling-Torgau’s work on the blood in tropical diseases.
I have freely consulted the various journals dealing with the subject of tropical medicine as to recent advances in this branch of medicine and I would particularly express my indebtedness to the Tropical Diseases Bulletin which should be in the hands of every student of tropical medicine, not only as an index to original papers but as a guide as to the advisability of consulting such papers. These abstracts are prepared by authorities in the different tropical diseases and many of the abstracts indicate the value or lack of value of the paper abstracted.
The tropical diseases are classified under those due to protozoa, those due to bacteria, those due to filterable viruses, infectious granulomata and tropical skin diseases. Sprue is classified as a food deficiency disease for the reason that the cure seems to rest solely in dietary treatment. Certain diseases which did not definitely belong to any of the above-named sections were taken up under diseases of disputed nature or minor importance. The second part of the book deals with the clinical diagnosis of tropical diseases.
CONTENTS
| PART I |
| TROPICAL DISEASES AND THEIR TREATMENT |
| DISEASES DUE TO PROTOZOA |
| CHAPTER I.—Malaria, 1. |
| CHAPTER II.—Blackwater fever, 55. |
| CHAPTER III.—The trypanosomiases, 66; African trypanosomiasis, 66; Brazilian trypanosomiasis, 80; Animal trypanosomiases, 84. |
| CHAPTER IV.—The tropical relapsing fevers, 86. |
| CHAPTER V.—Yellow fever, 97. |
| CHAPTER VI.—Infectious jaundice, 114. |
| CHAPTER VII.—Rat bite fever, 118. |
| CHAPTER VIII.—The leishmaniases, 121; Visceral leishmaniasis, 127; Cutaneous leishmaniasis, 135. |
| CHAPTER IX.—General considerations of dysentery, 141. |
| CHAPTER X.—Amoebic dysentery, 147. |
| CHAPTER XI.—Liver abscess, 164. |
| DISEASES DUE TO BACTERIA |
| CHAPTER XII.—Bacillary dysentery, 174. |
| CHAPTER XIII.—Plague, 188. |
| CHAPTER XIV.—Tularaemia, 213. |
| CHAPTER XV.—Cholera, 218. |
| CHAPTER XVI.—Malta fever, 237. |
| CHAPTER XVII.—Leprosy, 246. |
| FOOD DEFICIENCY DISEASES |
| CHAPTER XVIII.—Beriberi, 268; Rice and beriberi, 272; Ship beriberi, 285; Scurvy, 286; War oedema, 287. |
| CHAPTER XIX.—Pellagra, 291; The diagnostic triad, 302. |
| CHAPTER XX.—Sprue, 313; Hill diarrhoea, 316. |
| HELMINTHIC INFECTIONS |
| CHAPTER XXI.—Ancylostomiasis, 319. |
| CHAPTER XXII.—Filarial infections, 336; Filaria bancrofti, 341; Loa loa, 352; Onchocerca volvulus, 354; Dracunculus medinensis, 355. |
| [xii] CHAPTER XXIII.—The schistosomiases, 357; Japanese schistosomiasis, 364. |
| CHAPTER XXIV.—Minor helminthic infections, 368; Paragonimiasis, 368; Clonorchiosis, 371; Intestinal distomiasis, 373; Strongyloides stercoralis, 374. |
| CHAPTER XXV.—Table of important animal parasite diseases, 377; Protozoal diseases, 377; Trematodes, 379; Nematodes, 380; Cestodes, 381; Arthropodan diseases, 382. |
| INFECTIOUS GRANULOMATA OF THE TROPICS |
| CHAPTER XXVI.—Yaws, 384. |
| CHAPTER XXVII.—Gangosa, 395. |
| CHAPTER XXVIII.—Mycetoma, 399. |
| CHAPTER XXIX.—Granuloma venereum, 404. |
| TROPICAL SKIN DISEASES |
| CHAPTER XXX.—Tropical ulcer, 407. |
| CHAPTER XXXI.—Tinea imbricata, 411. |
| CHAPTER XXXII.—Tinea cruris, 414. |
| CHAPTER XXXIII.—Pinta, 416. |
| CHAPTER XXXIV.—Minor tropical affections of the skin, 418; Dermatophiliasis, 418; Tropical impetigo, 419; Piedra, 420; Cutaneous myiasis, 421; Creeping eruption, 422; Craw-craw, 424. |
| TROPICAL DISEASES OF DISPUTED NATURE OR MINOR IMPORTANCE |
| CHAPTER XXXV.—Verruga peruviana and Oroya fever, 425; Oroya fever, 425; Verruga peruviana, 428. |
| CHAPTER XXXVI.—Dengue, 431; Dengue-like fevers, 438; Phlebotomus or Pappataci fever, 438; Seven-day fever, 440; Sand-fly and three-day fever, 441; Six-day fever, 441. |
| CHAPTER XXXVII.—Tsutsugamushi or Japanese River fever, 442. |
| CHAPTER XXXVIII.—Spotted fever of the Rocky Mountains, 446. |
| CHAPTER XXXIX.—Typhus fever, 451. |
| CHAPTER XL.—Trench fever, 460. |
| CHAPTER XLI.—Heat stroke and heat prostration, 464. |
| CHAPTER XLII.—Climatic bubo, ainhum, goundou, juxta-articular nodules and visceral mycoses, 469; Climatic bubo, 469; Ainhum, 471; Goundou, 472; Juxta-articular nodules, 472; Visceral mycoses, 474. |
| PART II |
| DIAGNOSTICS OF TROPICAL DISEASES |
| CHAPTER XLIII.—Diagnostic problems and procedures, together with cosmopolitan diseases in the tropics, 477. |
| [xiii] CHAPTER XLIV.—Onset and the temperature chart in the diagnosis of tropical diseases, 491. |
| CHAPTER XLV.—Blood examinations in the diagnosis of tropical diseases, 504. |
| CHAPTER XLVI.—The circulatory, respiratory and lymphatic systems together with anaemia, haemorrhages and oedema in tropical diseases, 547. |
| CHAPTER XLVII.—Jaundice and the liver and spleen in tropical diseases, 557. |
| CHAPTER XLVIII.—The cutaneous system and the organs of the special senses, 561. |
| CHAPTER XLIX.—The urine and the genito-urinary apparatus in the diagnosis of tropical diseases, 570. |
| CHAPTER L.—The faeces and the alimentary tract in tropical diseases, 581. |
| CHAPTER LI.—The joints, bones and muscles in tropical diagnosis, 592. |
| CHAPTER LII.—Neurological considerations in tropical diseases, 598. |
PART I
TROPICAL DISEASES AND THEIR
TREATMENT
Benign Tertian Parasites
A1. Schizonts. 1. Normal red cell. 2. Young ring form. 3. Amoeboid or figure-of-eight form showing Schüffner’s dots. 4. Amoeboid form showing increased chromatin (twenty-four to thirty hours). 5. Segmentation of nucleus. 6. Nuclear halves further apart, red cells enlarged and pale. 7. Further division of nucleus. 8. Unusual division form. 9. Typical merocyte. 10. Rupture of merocyte liberating merozoites.
A2. Female gametes. 1. Young form showing solid instead of ring-form staining. 2. Half grown form. 3. Rapidly growing form with compact nucleus and clear vacuolated zone. 4. Full grown macrogamete showing eccentrically placed chromatin and much pigment in deep blue stained protoplasm. Male gametes. 1. Young form similar to female one. 2. Half grown form showing central chromatin. 3. Full grown microgametocyte showing large amount of centrally placed chromatin with light blue protoplasm surrounding. 4. Division of chromatin occurring in microgametocyte and developing in wet preparation. Note.—Chromatin division in gametes does not take place until blood is withdrawn. 5. Spermatozoon like microgametes developing from the microgametocyte. This only occurs in wet preparations or in the stomach of the mosquito.
B1. Schizonts. 1. Normal red cell. 2. Young ring form. 3. Older ring form. 4. Narrow equatorial band. 5. Typical band-form. 6. Oval form showing division of chromatin. 7. Early stage merocyte. 8. Daisy form merocyte.
B2. Male gametes. 1. Young solid form. 2, 3, 4. Developmental stages microgametocytes. 5. Flagellated body in wet preparation showing microgametes developing from microgametocyte. Female gametes. 1. Young oval form. 2. Somewhat older stage. 3 and 4. Mature macrogametocytes (same as benign tertian).
C1. Schizonts. 1. Normal red cell. 2, 3, 4, 5, 6. Young ring forms. These are hair-like rings and are the only forms besides crescents to be found in the peripheral blood. In very heavy infections or in smears from spleen the following forms are found. 7. Beginning division of chromatin. 8 and 9. Further division. 10. Merocyte.
C2. Female gametes. 1 and 2. Young macrogametes. 3. Older stage. 4. Development in red cell. 5 and 6. Fully developed female crescents showing clumping of pigment and rich blue colour. Male gametes. 1 and 2. Developing forms. 3 and 4. Fully developed microgametocytes. 5. Flagellated body developed in wet preparation.

SECTION I
DISEASES DUE TO PROTOZOA
CHAPTER I
MALARIA
Definition and Synonyms
Definition.—Malaria is a protozoal disease caused by three species of Plasmodium. In the clinically benign types of malaria we have that of benign tertian, due to P. vivax, with a tertian periodicity and that of quartan, due to P. malariae and showing a quartan or seventy-two hour periodicity. The clinically malignant type of malaria is due to P. falciparum, the parasite of malignant tertian or aestivo-autumnal malaria.
The benign malarial fevers are characterized by a frank chill and well marked distinctions of cold, hot and sweating stages. In malignant tertian there is an indefinite or dumb chill with prolonged hot stage. Diagnostic of malaria are periodicity, parasites and splenic enlargement. The malignant tertian parasite is the one responsible for the so-called cerebral and algid manifestations of perniciousness. Man is the intermediate host of the parasite while the sexual cycle or sporogony goes on in some species of mosquito of the anopheline subfamily, the definitive host.
Synonyms.—Remittent Fever, Intermittent Fever, Ague, Marsh Fever, Paludism, Jungle Fever.
French: Paludisme. German: Wechselfieber.
History and Geographical Distribution
History.—Hippocrates, who considered malaria as intimately connected with bile, divided the disease into quotidian, tertian and quartan, differentiating such types of fever from continuous fevers. It is interesting to note that Celsus recognized two types of tertian fever, the one benign and similar to quartan fever, the other far more dangerous, with a fever occupying thirty-six of the forty-eight hours, not entirely subsiding in the remission, but being only mitigated.
In the time of Caesar views were expressed by Varro that swamp air might be the cause of malaria and furthermore that animals, so small that the eye could not follow them, might transmit diseases by way of the mouth or nose.
In the view of our present knowledge it is remarkable that Lancisi, in 1718, should have associated marshes with the development of gnats, which insects he thought could not only introduce with their proboscides the putrefying organic matter of such swamps but animalcules as well.
In 1638 Countess del Chinchon, the wife of the Viceroy of Peru, was cured of an intermittent fever by the employment of the bark of certain trees which bark was introduced into Europe in 1640. The origin of the name cinchona is thus explained.
While Morton and Sydenham in 1666 noted the specific action of cinchona in certain fevers it remained for Torti, in 1753, by the use of cinchona, clinically to differentiate those fevers which were cured by cinchona from those which failed to yield to this specific. Quinine was not introduced until after 1820. Audouard, in 1803, was the first to draw attention to the splenic enlargement of malaria.
The views of Nott and Beauperthuis as to transmission of malaria and yellow fever by insects are considered under the latter disease.
In 1847 Meckel announced that the dark color of malarial organs was due to a pigment and in 1848 Virchow noted that this pigment was contained in cells. In 1875, Kelsch observed pigmented bodies in malarial blood and in 1880 came to the conclusion that these pigmented cells were diagnostic of malaria.
The year 1880 is the most important one in the history of malaria for on November 6, 1880, Laveran, at Constantine, first saw the parasites of malaria while carrying on investigations as to the origin of the pigmented bodies and melaniferous leucocytes. He not only noted the findings of spherical pigmented bodies but also of crescents and in particular the flagellation of the male gamete which demonstrated to him that these were living bodies.
The name Oscillaria malariae was proposed on account of the movements of the flagellate body, but had to be dropped as not valid, the generic name Oscillaria having been previously applied.
When these bodies were demonstrated to various Italian authorities, in 1882, they were thought by them to be degenerated red cells.
It may be stated that at this time the Italians, influenced by the work of Pasteur, were convinced that an organism, Bacillus malariae, reported by Klebs and Crudeli (1879) to have been isolated from water and soil of malarious districts, was the cause of malaria. This bacillus was said to be cultivable on ordinary media and to be capable, when injected into man, of producing malaria.
By 1885 the Italians were convinced that the bodies discovered by Laveran were the cause of malaria and Marchiafava, by staining with methylene blue, noted the ring forms and the increase in size up to that of the sporulating parasites. To Golgi we not only owe the discovery that the malarial paroxysm coincides with the period when the sporulating forms (merocytes) simultaneously reach maturity but also the exact working out of the cycle of quartan malaria. He even showed three stages of development of the parasites in a triple quartan. It may be stated that Golgi, Marchiafava and Celli are the ones to whom we owe our first knowledge of the existence of different species of parasites for different kinds of malaria. In these investigations they showed that as a rule they could reproduce a certain type of malaria by[3] injecting the blood of such a case of malaria into a well man. Gerhardt, in 1884, was the first to produce malaria by the injection of malarial blood. Laveran insisted all this time that there was but a single species of malaria. About this period a great deal of research was carried on as to the origin of malarial parasites and it was found that many animals harbored parasites similar to the malarial parasites of man. In 1891 the chromatin staining method of Romanowsky was introduced which by bringing out the variations in chromatin distribution led to more accurate study of species and cycles.
Our present exact knowledge as to the existence of 3 species of malaria is largely due to the careful examinations made by Koch of fresh and stained malarial blood preparations.

In 1894 Manson formulated the hypothesis of the mosquito transmission of malaria. He based this upon the fact that the flagellation of the male gamete does not take place for several minutes after the removal of the blood from the peripheral circulation. He also suggested that larvae might feed upon infected mosquitoes dying upon the water and thus acquire the disease.
Ross for two years had mosquitoes feed upon the blood of malarial patients which contained crescents but as he used insects of the genera Culex and Stegomyia he failed to observe development in the tissues of the mosquitoes. In 1897 he used 8 dappled-wing mosquitoes (Anopheline) and in two of these, upon dissection, he noted pigmentary bodies different from anything he had observed in hundreds of dissections of other mosquitoes. At this time he was forced to discontinue this work for about six months.
In 1886 Metschnikoff from observation of sporulating parasites in the brain capillaries at the autopsy of a malarial case considered them to be coccidial in nature. In 1892 Pfeiffer, studying the Coccidia showed that there was an endogenous cycle going on in the epithelial cells as well as the long known exogenous cycle connected[4] with the ingestion of oocysts passing out in the feces of an animal infected with coccidiosis. He suggested that malaria might similarly have an exogenous cycle as well as the well-known endogenous one. Opie noted hyaline and granular forms of parasites in the blood of crows and MacCallum, working with this malaria-like disease of birds (Halteridium), observed the fecundation of a granular female parasite by the flagellum-like process of the hyaline male cell.
In 1898, in India, working with a malarial disease of sparrows (Proteosoma), Ross infected 22 out of 28 healthy sparrows by mosquitoes which had previously fed on sick sparrows. He noted in the culicine mosquito employed for transmission the same cycle of development as that subsequently worked out for human malaria, in anopheline mosquitoes, by Grassi and Bignami, in Italy.
Koch’s great work in connection with malaria was to demonstrate that the malaria-like infections of other animals had no part in the causation of human malaria and that the malarial parasite could only circulate between man and certain mosquitoes.
In order to demonstrate conclusively the connection between infected mosquitoes and malaria Sambon and Low lived for three of the most malarious months of 1900, in one of the most malarious sections of the Roman Campagna, in a mosquito screened hut and did not contract malaria.
Infected mosquitoes were also sent to London from Italy and allowed to feed upon Doctor P. T. Manson and Mr. George Warren. After a period of incubation these volunteers came down with typical malaria with parasites in the blood.
In 1911 Bass first cultivated the parasites of malaria.
Geographical Distribution.—Malaria is so widely distributed over all parts of the tropical and subtropical world that it would require too much space to give its geographical distribution other than as given in the accompanying chart. The malaria belt may be said to extend from 60° N. to 40° S. Many of the islands of the Pacific are exempt.
Etiology and Epidemiology
Etiology.—There are at least three species of animal parasites which produce human malaria, Plasmodium vivax, the cause of benign tertian, P. malariae of quartan and P. falciparum of aestivo-autumnal. These parasites belong to the haemamoeba type of the order Haemosporidia, of the class Sporozoa and of the phylum Protozoa.
This type of Haemosporidia is characterized by invasion of red cells, amoeboid movement, pigment production and the extrusion of flagellum-like processes from the male sporont after the blood is taken from the animal and allowed to cool.
Other Haemosporidia which are very important in diseases of domesticated animals, but not for man, are those of the piroplasm type.
These parasites of the red cells do not produce pigment and do not “exflagellate.” It is to parasites of this type that some authorities have ascribed the cause of blackwater fever, a condition undoubtedly connected with malaria.
It has been thought proper by some to consider the malarial parasites as belonging to two genera, the genus Plasmodium, characterized[5] by round sexual forms and including P. vivax and P. malariae and the genus Laverania, characterized by crescent-shaped sexual forms and including but one species L. malariae, that of aestivo-autumnal malaria.
Craig recognizes a quotidian form and a tertian form for the aestivo-autumnal parasite. Manson formerly held the view that three different species of crescent-bearing parasites were concerned in malignant infections; one, of tertian periodicity, Laverania malariae, and two, of quotidian periodicity, L. praecox, a pigmented form, and L. immaculata, a form in which pigment is only observed in the crescent formation and does not exist in the ring form schizonts. He has abandoned this view. Stephens has noted a parasite which has more nuclear material than P. falciparum (P. tenue).
Malaria of Animals.—Other Haemosporidia of the haemamoeba type are found in birds, monkeys, bats, squirrels and possibly in reptiles (the parasites of reptiles, while intracorpuscular and pigment producing, do not exflagellate). Of particular interest is the so-called bird malaria or Proteosoma, a parasite very similar to the human malarial ones.
The life cycle of this parasite was demonstrated before that of the malarial parasites of man.
Although Koch in his work showed that these malaria-like parasites of other animals were not infectious for man, Fermi has recently carried out well-controlled experiments, by feeding laboratory bred anophelines on the blood of various animals showing such infections, and subsequently on men, with invariably negative results.
Accumulated experience shows that man is not susceptible to any of the animal malarias and that the three human species can only exist in man as an intermediate host and in certain species of anopheline mosquitoes as definitive hosts. Culicine mosquitoes never transmit malaria.
Malaria-Transmitting Mosquitoes.—In the United States, Cellia albimana, C. argyrotarsis, Anopheles crucians, A. quadrimaculatus and A. pseudopunctipennis are efficient transmitters of malaria. Rather remarkable is the experience of Beyer in New Orleans that A. crucians will only transmit P. falciparum while A. quadrimaculatus will transmit P. vivax and P. malariae, but not P. falciparum. Further experiments have shown that A. crucians will transmit P. vivax as well as P. falciparum.
As showing the uncertainty attaching to the question of a certain anopheline species being efficient hosts for malaria may be cited the case of A. punctipennis. This species has been frequently reported as incapable of transmitting malaria and quite recently Mitzmain reported experiments on 219 females of the species which had fed on crescent containing blood and which were dissected from three to thirty-eight days after such feedings with negative findings in stomach and salivary glands. Furthermore, these mosquitoes failed to transmit malaria to healthy persons. Control experiments with A. quadrimaculatus and A. crucians were successful. In June, 1916, Dr. King reported 33% of positive findings after dissection of A.[6] punctipennis which had fed on malignant tertian cases and 85% of success where the man bitten had benign tertian malaria. These results showed as high a degree of success as that obtained with the control A. crucians and A. quadrimaculatus.
From the above it must be evident that there are other factors involved besides that of the host species as both Mitzmain and King are expert epidemiologists.
A species which may be the chief transmitter in one country may be unimportant, though present, in another country. Thus Cellia albimana is the chief malarial transmitter of Panama although C. argyrotarsis is present. In Brazil the conditions are reversed, probably due to C. albimana thriving best where slightly brackish pools of standing water abound, as in Panama.
In the Philipines A. febrifer seems the important transmitter. It freely enters houses and is a vicious biter.
In India the species which seem most active in transmitting malaria are Myzomyia culicifacies and M. listoni; while in Africa, M. funesta is very efficient.
In Europe A. maculipennis and A. bifurcatus are important.
The following species of anophelines selected from the different genera are important transmitters of malaria.
Anopheles maculipennis.—Wings with four spots located at bases of both forked cells and of second and third longitudinal veins. No costal spots. Palpi yellowish brown and unbanded. Legs unbanded.
Anopheles punctipennis.—Wings with black costa showing yellow spots at apical third and at apex. The apical spot involves the first long vein and upper branch of first fork cell. The larger spot at the apical third passes through the first long vein and to the second vein just before it branches. In A. pseudopunctipennis the markings are as above but the fringe has yellow spots.
Myzomyia funesta.—Wings with four yellow spots on a black costa and two black line spots on third longitudinal vein. Palps with three white rings. Proboscis unbanded. Legs with faint apical bands.
Pyretophorus costalis.—Costa black with five or six small yellow spots. Palps with two narrow white bands and white tip. Femora and tibiae with yellow spots. Apical tarsal bands.
Myzorhynchus pseudopictus.—Black costa with two pale yellow spots. Wing fringe unspotted. Black palps with four pale bands. Apex of palps white.
Nyssorhynchus fuliginosus.—Black costa with three large yellow spots. Numerous black dots on the longitudinal veins. Palpi black with white tip and two narrow white bands. Last three hind tarsal segments white.
Cellia argyrotarsis.—Black costa with two distinct and several smaller white spots.
While anophelines are usually rural or at any rate preferring the suburbs of cities yet we can differentiate between domesticated and wild anophelines, these latter keeping away from man and consequently not playing a transmitting rôle.
Another factor in their becoming an efficient host appears to rest in the feeding habits of such anophelines, one which is voracious and fills and then ejects by rectum[7] the blood taken from the malarial patient is more apt to be a transmitter than a species less greedy.
By an efficient host is meant a species in which full development of the parasite takes place.
Life History of the Malarial Parasite
Malaria can be transmitted by subcutaneous or intravenous injection of the blood of a patient with the disease into a well person, the same type being reproduced.
Transmission of Malaria.—Such a method of transmission is only of scientific interest and the regular method is as follows: An infected anopheline at the time of feeding on the human blood introduces through a minute channel in the hypopharynx the infecting sporozoite of the sexual cycle.
When man is first infected by sporozoites we have starting up a nonsexual cycle (schizogony) which is completed in from forty-eight to seventy-two hours, according to the species of the parasite. The falciform sporozite bores into a red cell, assumes a round shape and continues to enlarge (schizont). Approaching maturity, it shows division into a varying number of spore-like bodies. At this stage the parasite is termed a merocyte. When the merocyte ruptures, these spore-like bodies or merozoites enter a fresh cell and develop as before.
Malarial Toxin.—At the time that the merocyte ruptures it is supposed that a toxin is given off which causes the malarial paroxysm.
Rosenau, by injecting, intravenously, filtered blood, taken from a patient at the time of sporulation of the parasites caused a malarial paroxysm. No parasites developed later. Another man who received a small amount of unfiltered blood allowed a slight paroxysm and four days later showed parasites in his blood. Hence the parasite will not pass through the pores of a Berkefeld filter.
Schizogony.—The nonsexual cycle goes on by geometric progression from the first introduction of the sporozoite, but it is usually about two weeks before a sufficient number of merocytes rupture simultaneously to produce sufficient toxin for symptoms (period of incubation). This cycle is termed schizogony. It is considered that there must be several hundred parasites per cubic millimeter sporulating to be capable of producing symptoms.
Gametes.—After a varying time, whether by reason of necessity for renewal of vigor of the parasite by a respite from sporulation, or whether from a standpoint of survival of the species, sexual forms (gametes) develop. Some think that sporozoites of sexual and nonsexual character are injected at the same time. It is usually considered,[8] however, that sexual forms develop from preexisting nonsexual parasites. The developing gametes are often termed sporonts. Strictly, the sexual parasites in the blood should be called gametocytes. The gametes take about twice as long to reach maturity as schizonts. The life of a crescent has been estimated as about ten days and that of the gametes of benign tertian and quartan about one-half this period.

Fig. 2.—Sexual (sporogony in mosquito) and nonsexual (schizogony in man) cycle of the malarial parasite. The sporogony diagram to the left shows in lower portion the fertilization of the female gamete by the microgamete. The vermiculus stage of the zygote is shown boring into the walls of the mosquito’s stomach to later become the more mature zygote packed with sporozoites as shown in the upper diagram of the developmental processes in the mosquito’s stomach.
Sporogony.—The gametes show two types the one which contains more pigment, has less chromatin, and stains more deeply blue is the female—a macrogametocyte; the other with more chromatin, less pigment, and staining grayish green or light blue is the male—a microgametocyte. When the gametes are taken into the stomach of the Anophelinae, the male cell throws off spermatozoa-like projections, which have an active lashing movement and break off from the now useless cell carrier and are thereafter termed microgametes. These fertilize the macrogametes and this body now becomes a zygote. (Following nuclear reduction with formation of polar bodies the macrogametocyte becomes a macrogamete). This process of exflagellation can be observed in a wet preparation under the microscope. There is first seen a very active movement of the pigment of the male gamete and finally long delicate bulbous-tipped flagellum-like processes are thrown off (exflagellated) and push aside the red cells by their progressive motion. MacCallum saw a female Halteridium fertilized by the microgamete, after which it was capable of a worm-like motion (vermiculus or ookinete).
By a boring-like movement the vermiculus stage of the zygote goes through the walls of the mosquito’s stomach, stopping just under the delicate outer layer of the[9] stomach or mid-gut. In three or four days after fertilization the zygote becomes encapsulated and is then often called an oocyst. It continues to enlarge until about the end of one week it has grown to be about 50µ in diameter and has become packed with hundreds of delicate falciform bodies. Some only contain a few hundred, others several thousand.
Zygotes.—In some of his observations Darling has noted that the zygote of benign tertian malaria grows larger and more rapidly than that of aestivo-autumnal and that the pigment is clumped rather than in belts or lines as with aestivo-autumnal. Darling has also noted that mosquitoes do not tend to become infected unless the gamete carrying man has more than 12 gametes to the cubic millimeter of blood. Rouband notes that the oocysts of P. vivax are feebly refractile with fine granules of gray pigment in loose chains while P. falciparum ones are highly refractile with large grains of black pigment. At a temperature of 25°C. vivax completes its cycle in 11 days while the zygote of the crescent requires 14 days. Apparently it is possible for a mosquito to carry both types of parasites.
The capsule of the mature zygote ruptures about the tenth day and the sporozoites are thrown off into the body cavity. They make their way to the salivary glands and thence, by way of the veneno-salivary duct, in the hypopharynx, they are introduced into the circulation of the person bitten by the mosquito, and start a nonsexual cycle. As the sexual life takes place in the mosquito, this insect is the definitive host and man only the intermediate host. The sexual cycle or sporogony in the mosquito takes about ten to twelve days.
Efficient Mosquito Hosts.—It must be remembered that only certain genera and species of Anophelinae are known malaria transmitters; thus Stephens and Christophers, in dissecting 496 mosquitoes of the species M. rossi, did not find a single gland infected with sporozoites.
With M. culicifacies, however, 12 in 259 showed infection. A mosquito which is capable of carrying out the complete sporogonous cycle is an efficient host and in the case of malaria the mosquito is the definitive host (sexual life of parasite).
Malarial Index.—Mosquito dissection is one method of determining the endemicity of malaria or the malarial index. There are two other methods: 1. by noting the prevalence of enlarged spleens, and 2. by determining the number of inhabitants showing malarial parasites in the blood. This index is best determined from children between two and ten years of age, as children under two show for a general average too high a proportion of parasites in the peripheral blood while those over ten years of age show too great an incidence of enlarged spleens.
Barber working in the Philippines with children from five to ten years of age obtained a spleen index of 13.3 and a parasitic index of 11.
As Before Stated there are Three Species of Malarial Parasites: 1. Plasmodium vivax, that of benign tertian—cycle, forty-eight hours; 2.[10] Plasmodium malariae, that of quartan—cycle, seventy-two hours; and 3. Plasmodium falciparum, that of aestivo-autumnal or malignant tertian—cycle of forty-eight hours.
Multiple Infections.—Variations in cycles may be produced by infected mosquitoes biting on successive nights, so that one crop will mature and sporulate twenty-four hours before the second. This would give a quotidian type of fever. In aestivo-autumnal infections anticipation and retardation in the sporulation cause a very protracted paroxysm, lasting eighteen to thirty-six hours; this tends to give a continued or remittent fever instead of the characteristic intermittent type.
Plasmodium Vivax.—In fresh, unstained preparations, taken at the time of the paroxysm or shortly afterward, the benign tertian schizont, or nonsexual parasite, is seen as a grayish white, round or oval body, whose outlines cannot be distinctly differentiated from the infected red cell. They are about one-fifth of the diameter of the red cell and are best picked up by noting their amoeboid activity. In about eighteen hours fine pigment particles appear and make them more distinct. After twenty-four hours the lively motion of the pigment and the projection of pseudopod-like processes, in a pale and swollen red cell, make their recognition very easy. When about thirty to thirty-six hours old the amoeboid movement ceases. Approaching the merocyte stage the pigment tends to clump into one or two pigment masses and one can recognize small, oval, highly refractile bodies within the sporulating parasite.
The gametes or sexual forms do not show amoeboid movement, but the fully developed gamete, which is generally larger than the red cells, has abundant pigment, which is actively motile in the male gamete and nonmotile in the female. The male gamete is more refractile, is rarely larger than a red cell and shows yellow-brown, short rod-like particles of pigment. About fifteen minutes after the making of a fresh preparation these male gametes throw out four to eight long, slender, lashing processes, which are about 15 to 20 microns long. These spermatozoon-like bodies now break off from the useless parent cell and with a serpent-like motion glide away in search of a female gamete, knocking the red cells about in their passage through the blood plasma.
The female gamete is larger than a red cell, is rather granular and has more abundant dark-brown pigment than the male.
Stained Smears.—In dried smears, stained by some Romanowsky method, as that of Wright, Leishman or Giemsa, we note small oval blue rings, about one-fifth of the diameter of the infected yellowish-pink erythrocyte. One side of the ring is distinctly broader than the rather fine opposite end, which seems to hold a round, yellowish-brown dot, the chromatin dot, and has a resemblance to a signet ring. These small tertian rings of the nonsexual parasites (schizont) are seen about the time of the commencement of the sweating stage of the paroxysm. Two chromatin dots in the line of the ring are rare as is also true of more than one ring in a red cell.
When the parasite is about twenty-four hours old we note that it contains much pigment and has an amoeboid or multiple figure-of-eight contour, is about three-fourths the size of a red cell and that the infected red cell is about one and one-half times as large as in the beginning and presents a washed-out appearance. It is an anaemic-looking cell. We also note, as characteristic of a benign tertian infection,[11] reddish-yellow dots in the pale red cell, which are known as Schüffner’s dots. These, practically, are characteristic for benign tertian.
A few hours before the completion of its forty-eight-hour cycle the contained pigment begins to clump, the chromatin to divide and, finally, we have a sporulating parasite, in which the 16 to 20 small, round, bluish bodies, with chromatin dots, are irregularly distributed over the area of the merocyte.

Fig. 3.—Plasmodium vivax.(Benign tertian) Development of schizonts of nonsexual cycle in peripheral blood of man. Red cell swollen and stains feebly. Note Schüffner’s dots. X 2200. (MacNeal after Doflein.)
The gametes, or sexual parasites, show a thicker blue ring and have the chromatin dot in the center of the ring. The pigmentation of the half-grown gametes is more marked than that of schizonts of equal size. The shape of the gametes is not amoeboid, as is that of the twenty-four to thirty-six-hour-old schizont, but round or oval. The full-grown gametes have the pigment distributed and the chromatin in a single aggregation—just the opposite of nonsexual parasites. The male gamete stains a light grayish blue and has a very large amount of chromatin, usually centrally placed. The female gamete stains a pure blue, has only about one-tenth as much chromatin as plasma, with the chromatin often placed at one side. The pigment of the female gamete is dark brown while that of the male is yellowish brown.

Fig. 4.—Plasmodium vivax. (Benign tertian.) Double infection of a red blood cell which is enlarged and shows Schüffner’s dots. X 2200. (MacNeal after Doflein.)
Plasmodium Malariae.—In fresh preparations the young quartan schizont has only slight amoeboid movement and, as development proceeds, the rather dark brown, coarse pigment tends to arrange itself peripherally about the band-shaped or oval parasite.
The infected red cell shows but little change. At the end of seventy-two hours the rather regular daisy form of the merocyte is more distinct than that of the benign tertian merocyte.
The distinctions between the male and female gametes are similar to those of the benign tertian gametes. In Romanowsky-stained smears it is difficult to distinguish the young quartan schizont from the benign tertian one but, after twenty-four hours, the tendency of the quartan schizont to assume equatorial band forms across a red cell of normal size and staining characteristics and without Schüffner’s dots makes the differentiation easy. In the fully developed sporulating parasite or merocyte the eight merozoites assume a regular distribution, giving it a daisy appearance.
The gametes show practically the characteristics of the benign tertian ones but are smaller.
Plasmodium Falciparum.—The young schizont of malignant tertian is extremely difficult to detect in fresh preparations, there being noted early in the rather long continued, hot stage, as small crater-like dots, about one-sixth of the diameter of a red cell which, however, show an active amoeboid movement.

Fig. 5.—Plasmodium vivax. Mature schizont and merocyte. Found in the blood just before and at onset of chill. X 2200. (MacNeal after Doflein.)
Malignant tertian blood tends to show rather marked vacuolation of the red cells and these central vacuoles have a resemblance to young ring forms. The malarial parasites are most often peripherally placed and they do not enlarge and diminish in size on focusing up and down as do the vacuoles.

Later on in the hot stage these ring-like dots enlarge to become about one-third of the diameter of a red cell, most often occupying the periphery of the infected red cell. About this time, or at the very commencement of the pigmentation, the schizont-containing red cells disappear from the peripheral circulation so that the further development is rarely observed in blood specimens.
The infected cell is brassy in color and shrunken in shape—it shows evidences of degeneration. The gametes appear as crescent-shaped bodies, which are absolutely characteristic of malignant tertian, the male gamete being more hyaline and delicate while the female one is more granular and larger.

Fig. 7.—Plasmodium falciparum. (Malignant tertian) Nonsexual cycle in blood and internal organs of man. Note multiple infections of single red cell. (From MacNeal after Doflein.)
In Romanowsky-stained preparations we see, while the fever is sustained, small hair-like rings, with geometrical outline, with frequently two chromatin dots in one end of the ring and a single red cell often showing two or more of these young rings. The rings are often seen as if plastered on the periphery of the red cells or as if having destroyed a rounded section of the rim of the red cell. As the fever declines the rings tend to disappear from the peripheral circulation. The infected red cells often show polychromatophilia and distortion.

Fig. 8.—Tertian malarial parasite, one red cell showing malarial stippling. (Todd.)
Fig. 9.—Estivo-autumnal malarial parasites, and small ring forms and crescents. (Todd.)
In old aestivo-autumnal cases, or those with severe infection, we may see adult rings and merocytes, which latter are smaller than those of benign tertian, show from 10 to 12 irregularly placed merozoites and a sharply clumped mass of pigment.
The gametes are the striking crescent-shaped bodies and these show the distinctions of blue-staining for the female, with lighter gray-blue to purplish staining and[14] abundance of chromatin for the male. The chromatin staining of crescents does not stand out so well as that of the round form gametes of benign tertian and quartan.
The black pigment of the female tends to be clumped toward the center while the rather generally distributed pigment of the male is reddish brown rather than black in a stained preparation.
This variation of pigment color may be due to the effect of chromatin staining, as the black of the pigment is the same in male and female gametes in fresh blood preparations.
Stained Smear Preferred.—As regards differentiation of species and cycle the examination of stained smears is more satisfactory and definite, as well as less time consuming. Still, one obtains many points of differentiation in the fresh preparation and should study such a preparation while carrying out the staining of his dried smear.
| Unstained Specimen (fresh Blood) | |||
| P. vivax (benign tertian) | P. malariae (quartan) | P. falciparum (malignant tertian) (aestivo-autumnal) | |
| Character of the infected red cell. | Swollen and light in color after eighteen hours. | About the size and color of a normal red cell. | Tendency to distortion of red cell rather than crenation. Shriveled appearance. (Brassy color.) |
| Character of young schizont. | Indistinct amoeboid outline. Hyaline. Rarely more than one in r.c. Active amoeboid movement. One-third diam. of r.c. | Distinct frosted glass disc. Very slight amoeboid motion. | Small, distinctly round, crater-like dots not more than one-sixth diameter of red cell. Two to four parasites in one red cell common. Shows amoeboid movement until appearance of pigment. |
| Character of mature schizont. | Amoeboid outline. No amoeboid movement. | Rather oval in shape. Sluggish movement of peripherally placed coarse black pigment. | Only seen in overwhelming infections. Have scanty fine black pigment clumped together. |
| Pigment. | Fine yellow-brown, rod-like granules which show active motion in one-half-grown schizont. Motion ceases in full-grown schizont. | Coarse almost black granules. Shows movement only in young to half-grown schizont. | Pigmented schizonts very rare in peripheral circulation except in overwhelming infections. Tends to clump as eccentric pigment masses almost black in color. |
| Stained Specimen | |||
| P. vivax (benign tertian) | P. malariae (quartan) | P. falciparum (malignant tertian) (aestivo-autumnal) | |
| Character of infected red cell. | Larger and lighter pink than normal red cell. Shows “Schüffner’s dots.” | About normal size and staining. | Shows distortion and some polychromatophilia and stippling. Rarely we have coarse cleft-like reddish dots—Maurer’s spots. |
| Character of young schizont. | Chromatin mass usually single and situated in line with the ring of the irregularly outlined blue parasite. | Rather thick round rings which soon tend to show as equatorial bands. | Very small sharp hair-like rings, with a chromatin mass protruding from the ring. Often appears on periphery of red cell as a curved blue line with prominent chromatin dot. Frequently two chromatin dots. |
| Character of half-grown schizont. | Vacuolated or Fig. 8 loop-like body with single chromatin aggregation. Schüffner’s dots. | More marked band forms stretching across r.b.c. | Not often found in peripheral circulation. Chromatin still compact. |
| Character of mature schizont. | Fine pigment rather evenly distributed in irregularly outlined parasite. | Coarse pigment rather peripheral- ly arranged in an oval parasite. | Very rarely seen in peripheral circulation in ordinary infection. Pigment clumps early. |
| Character of merocyte. | Irregular division into 15 or more spore-like chromatin dot segments. | Rather regular division into eight or ten merozoites—Daisy. | Sporulation occurs in spleen, brain, etc. Rarely in peripheral circulation. 6 to 10 irregularly placed merozoites. (In culture 32.) |
| Character of macrogamete. | Round deep blue. Abundant, rather coarse pigment, chromatin at periphery. | Round, similar to P. vivax but smaller. | Crescentic, pure blue pigment clumped at center, chromatin scanty and in center. |
| Character of microgametocyte. | Round, light green-blue, pigment less abundant, chromatin abundant and located centrally or in a band. | Round like P. vivax. | More sausage-shaped than crescent. Light grayish blue to purplish. Pigment scattered throughout. Chromatin scattered and in greater quantity but difficult to stain. |
Central vacuolation of red cells is common in malarial anaemia and may be mistaken for nonpigmented parasites.
Malarial rings are usually peripheral and do not vary in size as one focuses up and down as do the central vacuoles.
Quinine-affected Parasite.—A very puzzling but well-recognized finding in cases treated with quinine or salvarsan is the so-called quinine-affected parasite. Such parasites lack definiteness of outline and show poor chromatin staining. The gametes do not seem to show these effects from the drug.
Certain questions connected with the life history of the malarial parasite in man which are of interest.
1. Extracellular location.—It is usual to consider the parasite as developing within a red cell and in this position to destroy the red cell. Rowley-Lawson, however, thinks that the parasites are exclusively extracellular and that they adhere to the red cells by loop-like pseudopodia which encircle a portion of the red cell and digest the haemoglobin of such an area.
2. Relapses.—There are several views as to the etiology of relapses in malaria. These views are taken up under relapses (see page 35).
3. Malarial toxin.—Nature of the toxic material thrown off by the parasite at the time of simultaneous sporulation. Rosenau’s experiments tend to show that there is a fever-producing toxin thrown off at this time. Other authors have thought that a haemolysin and an endotheliolysin were thrown off at the same time. Brown considers that the pigment produced by the parasite, in its metabolism of the haemoglobin of the red cell, may act as a haemolysin, he having found that intravenous injections of haematin were capable of producing marked anaemia. It is well known that a far greater number of red cells are destroyed in a paroxysm than would be accounted for by the actual percentage of red cells destroyed by parasites. The endothelial cells take up actively this malarial pigment or haemozoin and are damaged or destroyed thereby. Haematin injections also tend to destroy leucocytes and platelets.
Rowley-Lawson is of the opinion that the greater red cell destruction than would be represented by percentage of cells showing parasites is explained by parasites migrating from cell to cell so that many red cells may be destroyed by a single parasite.
4. Transmission to larvae.—There has been an idea that sporozoites might enter the ovaries and ova as well as the salivary glands so that a second generation of mosquitoes might transmit malaria. There is no proof that such a method is ever operative.
5. Congenital malaria.—There has been some question as to the possibility of congenital malaria. Heiser has recently reported the case of an infant which showed crescents in its blood by the end of one week from birth. The mother showed the same infection and the child must have been infected through the placental circulation.
Clark in numerous examinations of the blood of the new-born failed to find infection even when the mother’s blood teemed with parasites. In one case where the child showed infection shortly after birth there had been an accident to the placenta and he believes that instances of so-called congenital malaria are to be explained in this way.
6. Cultivation of parasite.—As to cultivation of malarial parasites. Bass takes from 10 to 20 cc. of blood from the malarial patient’s vein in a centrifuge tube which[17] contains 1/10 cc. of 50% glucose solution. A glass rod, or a piece of tubing extending to the bottom of the centrifuge tube is used to defibrinate the blood. After centrifugalizing there should be at least one inch of serum above the cell sediment. The parasites develop in the upper cell layer, about 1/50 to 1/20 inch from the top. All of the parasites contained in the deeper-lying red cells die. To observe the development, red cells from this upper 1/20 inch portion are drawn up with a capillary bulb pipette.
Should the cultivation of more than one generation be desired, the leucocyte upper layer must be carefully pipetted off, as the leucocytes immediately destroy the merozoites. Only the parasites within red cells escape phagocytosis. Sexual parasites are much more resistant. Bass thinks he observed parthenogenesis. The temperature should be from 40° to 41°C. and strict anaerobic conditions observed. Aestivo-autumnal organisms are more resistant than benign tertian ones. Dextrose seems to be an essential for the development of the parasites.
Bass considers that P. vivax has a disc-like structure which enables it to squeeze through the brain capillaries while adult schizonts of P. falciparum have a solid oval form which causes them to be caught in the capillaries.
The Thompsons have rather simplified the method of Bass. They draw 10 cc. of blood into a test tube containing the usual amount of glucose solution. They then defibrinate the blood by stirring with a thick wire for about five minutes and remove the wire with the adhering clot. They then pour this defibrinated blood into several small sterile test tubes, which should contain at least a one-inch column. Rubber caps are adjusted over the cotton plugs and the tubes placed in the incubator. They note the tendency of cultures of P. falciparum to agglutinate which is not true of P. vivax.
They think this agglutination the great cause of the plugging of capillaries in pernicious malaria. They note 32 merozoites as maximum number in sporulation of P. falciparum while P. vivax has usually 16 or more, but never as many as 32.
This would explain the shorter incubation period of malignant tertian. The pigment of P. falciparum clumps much earlier in the developing schizont than that of P. vivax and is much coarser and more discrete.
While Bass thought he noted parthenogenesis in cultures others have failed to observe any evidence of it.
7. Immunity.—As to immunity. There is no real immunity to malaria, it is a continuance of the infection, but the parasites are not in sufficient numbers to give rise to fever. If, however, the patient becomes chilled or fatigued or otherwise depressed, fever results.
This apparent immunity is also kept up by reinfection, because if natives leave the locality for a length of time they lose it. Patients who show this apparent immunity to one form of malaria have no such resistance to the other types. Bass states that immune bodies are produced in malaria and that immune processes contribute to control of the infection, but that it is not lasting and is not effective against new infection.
8. Perniciousness.—Causes of perniciousness. This is taken up under perniciousness in malaria. (See page 31.)
9. Quinine-affected parasite.—Effect of quinine on malarial parasites. It is usually thought that the merozoites at the time of being thrown off from the merocyte[18] are most vulnerable, while the gametes are only slightly affected, if at all. Still, the young forms from which gametes develop are destroyed. Quinine causes parasites to disappear from the peripheral circulation and produces degenerative changes in such parasites as may remain. Bass thinks that quinine makes the red cell permeable to the lytic action of serum. Anaemia may cause degenerative changes in parasites similar to that from quinine.
10. Anaphylaxis and the paroxysm.—Abrami has brought forward evidence in favor of the malarial paroxysm being due to the outpouring of merozoites into the blood plasma which act as foreign antigen. It is noted that the dissemination of merozoites takes place some hours before the cold stage which is one of the manifestations of anaphylactic shock. They note a leucopenia and lowering of the blood pressure preceding the paroxysm as evidence of a haemoclastic crisis.
The Anopheline Mosquito
The ova of culicine mosquitoes are usually deposited in a scooped-out raft-like mass of about 250 eggs set vertically. The raft is easily seen with the eye, being about ⅕ inch long. The anopheline eggs are oval in shape with pleated air cell projections laterally. They are laid upon the surface of the water, to the number of about 100, in star, triangle or ribbon patterns. The egg stage is two to four days but shorter, however, in the tropics.
The larval stage is the most important one to be acquainted with because in this stage one can most readily distinguish the anopheline or possible malaria transmitter from a culicine species. One can more readily and quickly make a survey for anophelines by examining the collections of water for larvae than in any other way. The anopheline larva seems to prefer the surface, on which it lies flat and out of the water. To keep it from turning over on its long axis, it has little rosette-like hair tufts on the dorsal surface of the 5 or 6 middle abdominal segments (palmate hairs). There are feathered lateral hairs projecting from thorax and abdominal segments. The head is very small in comparison with the thorax and can be rotated with lightning-like rapidity. There is no projecting breathing tube or syphon from the next to the last abdominal segment, as is characteristic of Culex, Stegomyia or any other culicine genus.
In addition, culicine larvae do not float parallel to the surface of the water, but hang suspended at an angle, with only the tip of the syphon pushed upward to the surface. The lateral hairs or bristles are not feathered and the head is much larger than that of the anopheline larvae. It is the fact of the surface position of these anopheline larvae which enables them to worm their way over film layers of water or between blades of grass, in grass or rush studded pools or swamps.
In the pupal stage it is rather difficult to differentiate species of mosquitoes from each other, so that, other than to recognize that the bloated shrimp-like body is a mosquito pupa, is unnecessary.

Fig. 10.—In the above figure note the culicine egg raft, 45° angle position of syphonate larva, parallel attitude of resting mosquito, nonbulbous palpi of male and short palpi of female as contrasted with the anopheline star or ribbon arrangement of eggs, horizontal attitude of asiphonate larva, bradawl attitude of resting mosquito, spotted wings, bulbous palpi of male and long palpi of female mosquito. (From Jordan after Kolle and Hetsch.) MacNeal.
Differentiation of Culicinae and Anophelinae
It is impossible even for an entomologist to determine the species of mosquitoes without recourse to elaborate keys and tables. It is a comparatively easy matter, however, to decide as to whether the mosquito is a probable malaria transmitter or not.
The male anopheline.—While certain characteristics of the male are used to separate the Aedinae from other subfamilies, yet it is only with the female that we concern ourselves in differentiating the Culicinae from the Anophelinae. Therefore, it is first necessary to distinguish the male from the female. If the antennae have not been torn off, this can be decided by the highly adorned plumose antennae of the male, those of the female being sparsely decorated with short hairs. The palpi of the male Anopheles tend to be clubbed, while those of the Culex are straight. If the antennae have been broken off, look for the claspers at the end of the abdomen.
Male mosquitoes do not feed on blood but on fruits and flowers instead. The puncturing parts of the male are not sufficiently resistant to penetrate the skin.
The female anopheline.—Having determined that the insect is a female, we then proceed to place it either in the subfamily Culicinae or Anophelinae by a study of the relative length of the palpi to the proboscis. If the palpi are much shorter than the proboscis, it belongs to the Culicinae; if about as long or longer, to the Anophelinae. The palpi of the female Megarhininae are also long, but the proboscis is curved.
Having settled on the subfamily, we separate the genera by considering such points as character and distribution of scales on back of head, wings, thorax, and abdomen; banding of proboscis, legs, abdomen, and thorax, shape of scales on wings, and location of cross veins.

Anophelinae show abundant upright forked scales on occiput. The mesothorax shows sparse hairs or scales with a smooth scutellum. As a rule, the wings are spotted (dappled) and the location of these spots gives the best clue to the different[21] species of the genera. With the exception of Bironella the first submarginal cell is large. This cell is longer than the second posterior one.
In the resting position Culex allows the abdomen to droop, so that it is parallel to the wall. The angle formed by the abdomen with head and proboscis gives a hunchback appearance.
Anopheles when resting on a wall goes out in a straight line at an angle of about 45°. It resembles a bradawl.
The scutellum of Anopheles is simple, that of Culex trilobed. Anopheles has but one spermatheca; Culex has three.
| Anophelinae | ||
| ┏ | 1. Scales on wings, large and lanceolate. Anopheles. Palpi only slightly scaled. | |
| 1. Scales on head only; hairs on thorax and abdomen. | ┃ | 2. Wing scales small and narrow and lanceolate. Myzomyia. Only a few scales on palpi. |
| ┗ | 3. Large inflated wing scales. Cycloleppteron. | |
| 2. Scales on head and thorax (narrow curved scales). Abdomen with hairs. | [ | 1. Wing scales small and lanceolate. Pyretophorus. |
| ┏ | 1. Abdominal scales only on ventral surface. Thoracic scales like hairs. Myzorhynchus. Palpi rather heavily scaled. | |
| 3. Scales on head and thorax and abdomen. Palpi covered with thick scales. | ┃ | 2. Abdominal scales narrow, curved or spindle-shaped. Abdominal scales as tufts and dorsal patches. Nyssorhynchus. |
| ┗ | 3. Abdomen almost completely covered with scales and also having lateral tufts. Cellia. 4. Abdomen completely scaled. Aldrichia. | |
Note.—Of the above genera only Cycloleppteron and Aldrichia are unproven malarial transmitters.
The female anopheline mosquito alone bites man, the male feeding on fruits and flower juices. The female absolutely requires blood for the development of her eggs after fertilization by the male mosquito.
The anopheline mosquito bites at night or toward evening and selects some dark place or dark colored wall to sleep against during the day. Hence the advantage of a buff colored wall interior. It is well to remember that the malarial incidence may be kept down by killing the mosquitoes inside of a house by striking them with a folded paper or piece of wire gauze on a handle (fly swatter).
It is not a bad plan to have a dark colored surface in a room to attract them and make their destruction easy.
Anophelines do not like wind and seek protection of underbrush. As regards distance of flight from breeding places Metz has noted that A. crucians were not distributed generally over 7000 feet and rarely were found between 7000 and 9000 feet beyond which distance they were not found. Some anophelines get accustomed to feeding exclusively on animals. Mosquitoes may hibernate through the winter and[22] possibly cause new infections the following spring. Cases of malaria in the spring are however usually due to relapses. Mitzmain’s negative experiments with hibernating mosquitoes prove man to be the winter carrier.

The malarial zygote will not develop in the stomach of the mosquito if the temperature is below 16°C. (60°F.). It would seem that the zygote of P. malariae will develop at a lower temperature than that of the other two species, P. falciparum requiring the highest temperature.
Our views as to temperature requirements for the development of zygotes in the mosquito must be changed as King has recently shown that P. vivax sporonts will survive exposure to temperatures of 30°F. for two days and P. falciparum temperatures of 35°F. for one day. This proves that temperatures approximating freezing ones will fail to destroy the parasites of hibernating mosquitoes.
Wenyon has found experimentally that mosquitoes which had fed on malarial blood and kept at incubator temperatures for a week to allow development of zygotes showed inhibition of development of zygotes when kept at temperatures corresponding to hibernating ones. This treatment did not kill the zygotes but[23] complete development took place when subsequently the mosquitoes were again subjected to incubator temperatures. From this it would seem that the zygotes remain viable during the winter hibernation. This is at variance with Mitzmain’s views who regarded hibernation as destructive to zygotes.

The mosquito does not seem to suffer from her malarial infection—quite different from the serious affection that filariasis causes in the mosquito.
Epidemiology.—This matter has been considered rather extensively under the historical and etiological discussions.
It may be stated however that the requirements for the spread of malaria are: (1) Men who have sexual forms of the malarial parasite in their peripheral circulation; (2) efficient anopheline hosts, and (3) an atmospheric temperature above 60°F. (16°C.).

It is a well recognized fact in the tropics that the natives seem to have an immunity to malaria yet may carry parasites in their circulation and serve as carriers. The native children to a striking degree harbour parasites and to them malaria is a prime cause of death. After repeated infections, if not fatal, a temporary immunity is acquired. Many localities in the tropics owe freedom from malaria to an absence of anophelines, as for instance Barbadoes. Again malaria-bearing mosquitoes may acquire the habit of feeding on animal blood other than that of man. It is well recognized that rural populations are more liable to malaria than those of towns and as the population of a country moves to the industrial centres human blood may become difficult to obtain and the anophelines turn to other sources of blood supply. It has been suggested that mosquitoes may suffer from other infections which may be inimical to the development of malarial zygotes (black spores of Ross). Anophelines bite chiefly at sunset and at night from which fact there would seem to be some value in shutting the windows towards nightfall as is the custom in many malarious parts of the world.
Pools containing a border growth of grass or rushes are often selected by anophelines for depositing eggs. The small fish or tadpoles, which prey on the larvae, cannot work their way through the obstacles and, again, petroleum oil cannot be easily distributed in a network of grass. Anophelines of different species and of different countries seem to vary in their selection of water for depositing their eggs. We should not generalize but go out and search for breeding places.

Anophelines seem to prefer small collections of water or sluggish clear streams. The pools made by excavations following railway or other similar construction are favorite breeding places. Proper cultivation of rural districts makes the country more healthful and Carter has stated that tile drainage is the key to rural malaria control.
The most practical method for the identification of anopheline species is to collect the larvae and later to study the adults which develop from the pupae. On the whole culicines do not seem to object to foul collections of water while anophelines avoid such breeding places.
Pathology and Morbid Anatomy
The pathological lesions are those connected with the destruction of enormous numbers of red cells, not only each infected red cell being[26] destroyed but others not so parasitised. There has been an idea that at the time of sporulation and rupture of the merocyte a pyrogenetic toxin was given off and along and with this there were haemolysins and endotheliolysins. Following Brown we are justified in thinking that the malarial pigment (melanin or haemozoin) can act as a haemolysin and by being taken up by endothelial cells bring about their degeneration with associated capillary haemorrhages. All three factors—red-cell destruction by parasites, haemolytic action on red cells and capillary haemorrhages lead to anaemia.

Fig. 16.—Digestive tract of Anopheles the stomach of which is covered with numerous zygotes or oocysts of Plasmodium falciparum. c, cloaca; mt, malpighian tubules; o, oocyst; s, stomach; sb, sucking bladders or pumping organ; sg, salivary gland. (MacNeal from Doflein, modified after Ross and Grassi.)
The brain has a leaden hue caused by the black pigment. As discussed under pernicious manifestations the blocking of the capillaries may be explained in several ways. When examining sections of a malarial brain one often encounters punctiform haemorrhages.
The spleen is enlarged and the surface dark. In acute cases it may be diffluent instead of hard, as in ague cake. Microscopic sections show a striking absence of pigment in the Malpighian corpuscles, the haemozoin being pushed off into the surrounding spleen pulp. Bone marrow is dark from deposit of pigment. In the liver the endothelial and Kupfer cells are packed with black pigment. The parenchymatous cells do not contain this pigment but may show grains of a yellow pigment, haemosiderin, which gives the iron reaction. Haemozoin, although it contains iron, does not give this reaction. Haemozoin is soluble in alkalis, but not in alcohol while haemosiderin is soluble in alcohol but not in alkalis.
The splenic blood is more rich in haemozoin than that of the other vessels, this indicating the spleen as the place of destruction of infected red cells or as the nursery for the development of malarial parasites. As a matter of fact splenectomy may cure an old malarial cachectic.
The finding of pigmented mononuclears or pigmented parasites in a cross section of a blood vessel makes for a diagnosis of a malarial infection.
Malarial manifestations are common in tropical autopsies and one must be very chary about reporting malaria as the real rather than contributing cause of death.
There is usually a marked increase in large mononuclears in malaria and if this is noted along with a leucopenia it is very suggestive. Melaniferous leucocytes occur in malaria only.
The kidneys may show degenerative changes and the presence of urobilin in the urine is an important indication of latent malaria.
Symptomatology
Clinically, we have two types of malarial paroxysms, (1) Those presenting a cold stage, followed by a hot stage, with a terminal sweating stage. Such attacks are brought about by the benign infections which include the benign tertian and the quartan. Owing to the fact that in such paroxysms the temperature makes a critical fall to normal or subnormal readings such fevers are frequently designated intermittent fevers.

Fig. 17.—Diagram of the temperature chart of a double tertian malarial fever showing the succeeding development of two generations of parasites, causing thereby a quotidian fever. The solid line, A, shows the development of the generation of parasites first introduced and the dotted line, B, the cycle of the generation introduced later on.
While these benign infections rarely or never exhibit pernicious manifestations, they may, equally with the more dangerous aestivo-autumnal parasite, lead to the production of malarial cachexia, in which the clinical manifestations are similar whether produced by a benign or malignant species.
(2) Those in which the succession of cold, hot and sweating stages is lacking. There is not the frank well-defined chill of the former group,[28] so that the term dumb chill is frequently applied. With the possible exception of the first paroxysm the temperature tends to remain well above normal giving a continuous, or at any rate a remittent type of fever, instead of the intermittent temperature curve of the benign infections. The designation remittent fever, is often applied to such fevers. Clinically there is a resemblance to typhoid fever.
Such malarial fevers are caused by the small hair-like ring parasite with its crescent sexual forms. There are many designations for this type of malarial fever of which the best recognized are: malignant tertian, subtertian, aestivo-autumnal and tropical. It is preëminently the malarial fever of the tropics and, from its appearing in temperate climates chiefly in the late summer and through the autumn months, received from the Italians the designation aestivo-autumnal.
Such fevers were called subintrant by Torti because the succeeding paroxysm set in before the completion of the long-continued preceding one. This type of fever was greatly dreaded. The designation malignant tertian is to be preferred as indicating the greater seriousness of this type of malaria.
Incubation Period
Depending in great part on the number of sporozoites introduced by one or more infecting anophelines at the time of biting we have with quartan fever (8-12 merozoites) a period of incubation of approximately three weeks, for benign tertian (16-24 merozoites) two weeks and for malignant tertian (32 merozoites in culture) eight to twelve days. These periods however may be much longer.
Prodromata
There may be prodromata of the nature of malaise, vague muscular pains, headache and anorexia, possibly showing a periodicity in their appearance or intensity.
It is only when a sufficient number of parasites sporulate simultaneously and pour out into the circulation sufficient toxic material to cause a well-marked paroxysm that such occurs—with less poison we may only have vague suggestions of an attack of ague.
In a large proportion of cases there are no prodromata, they begin with a sudden onset.
Malarial paroxysms show a preference for the forenoon or at any rate tend to occur in the early afternoon, rather than in the evening.
Mixed and Multiple Infections
When there are two generations of tertian parasites, each maturing on successive days, we have a paroxysm every day—a quotidian fever. Such a tertian infection is called a double tertian. In quartan infections, with the seventy-two-hour cycle of development, if we have two generations of parasites sporulating on succeeding days, but with an apyretic day intervening, we have a double quartan. If three generations of quartan parasites sporulate on three successive days we have a triple quartan infection. When two species of parasites are present in the same case we have a mixed infection. Mixed infections of malignant tertian and benign tertian are the most common, next, those of quartan and malignant tertian and very rarely those showing quartan and benign tertian. All three species have been found in a single individual.
Clinical Types
A Typical Benign Tertian or Quartan Paroxysm.—(Other than for the difference in periodicity the paroxysms of these two malarial infections are alike.)
The ague attack generally commences with malaise and slight headache, frequently accompanied by yawning and stretching. Chilly sensations radiating from the spinal column to the extremities and the jaws give way to actual chill with shaking body and chattering teeth, face pinched and bluish and cutis anserina.
The pulse is frequent, small and of rather high tension, there is increased frequency of urination and nausea and vomiting may be present.
Notwithstanding the fact that the rectal temperature is steadily rising five or six degrees during this cold stage there is a desire on the part of the patient to cover himself with all the wraps obtainable.
The cold stage, which usually lasts from twenty to sixty minutes, is succeeded by the hot stage.
At first there is a feeling of slight relief from the misery of the chill but this is soon lost sight of in the increasing headache and feeling of intense heat.
The previously welcome blankets are cast aside. The face now becomes flushed, the eyes shining, and the pulse more full. Epigastric discomfort, nausea and vomiting are apt to become more prominent in this stage. The patient often complains of a throbbing headache. It is at this time that he may become slightly delirious. A sense of tension or even pain may be experienced in the region of the spleen,[30] which organ will be found tender even if not already palpable. Herpes about the nose and lips is almost as common as in lobar pneumonia.
An attending bronchitis is not uncommon.
The fever remains high, from 105° to 106°F., and continues so elevated for from four to six hours to be succeeded by the sweating stage. In this the dry skin becomes moist and perspiration breaks out first on the forehead to be followed by a more or less marked profuse sweating of the entire body. The pulse becomes slower, the temperature falls rapidly and the patient falls asleep to awake slightly exhausted but feeling well.

This feeling of well-being continues during the fever-free day which is often referred to by a patient as “my good day.”
The sweating stage lasts usually about four hours so that the entire paroxysm of cold, hot and sweating stages occupies approximately eight to twelve hours.
While most cases of the benign infections show the typical stages yet we meet cases where the cold and sweating ones are absent or but slightly marked.
Blood examination will show the parasites of the benign infections to be in the peripheral circulation during the entire apyrexial period. During the paroxysm we have a moderate leucocytosis and during the afebrile period a leucopenia with an increased percentage of large mononuclears.
Billet thinks that quartan paroxysms can be distinguished from benign tertian ones by their showing a less abrupt fever rise and a more rapid fall of temperature with a shorter duration of the paroxysm, four or five hours as against eight to twelve hours for benign tertian.
A Typical Malignant Tertian Paroxysm.—The characteristic features of the paroxysm are slight chilliness instead of a frank chill, prolonged and intensified hot stage, lack of marked terminal sweating and a tendency to exhibit a continuous or at least remittent fever curve instead of the distinct intermittence, with an apyrexial period, of the benign infections.
During the period of the remittence the patient fails to experience a sense of well-being. He is sick and does not have a “well day.”
The temperature of a malignant tertian paroxysm may fall to normal during the first attack but succeeding attacks only show the tertian periodicity by an exacerbation of the more or less continuous fever.
In these cases the temperature rise is gradual rather than abrupt and the fall rather by lysis than crisis.
The paroxysm lasts from twenty to thirty-six hours instead of ten hours.
To explain the continuous type of fever it is often stated that anticipation and retardation are characteristic of malignant tertian infections. This simply means that the new paroxysm tends to come on before the tertian periodicity of forty-eight hours has expired and, having appeared, tends to delay its termination. At any rate there is an extreme irregularity in the course of the paroxysm. These attacks are often termed “dumb chills” and are greatly dreaded.
The onset is insidious, occurring as a rule in the forenoon or early afternoon, with rarely a chill but only chilly sensations. The headache and backache are severe, the face is flushed, the pulse quickened and the thirst urgent.
The patient feels more prostrated and ill than does one in a benign paroxysm and there is a distinct tendency to mental confusion or delirium. Nausea and vomiting may be prominent features of an attack. At times an apathetic state may suggest typhoid fever. In these malignant malarial attacks the spleen is palpable and very tender. There is also a sense of weight in the region of the liver.
In a blood examination one is not apt to find any other parasites than the young hair-like ring forms which begin to appear a few hours after the onset of the paroxysm. The rings may be observed to broaden, but prior to that development in which pigment would appear in the ring, the parasite-containing red cell is caught in the capillaries of spleen or other organs. The finding of young ring forms while fever continues is suggestive of a malignant tertian infection.
In the absence of quinine administration the finding of parasites is to be expected in benign tertian and quartan infections, but with the tropical parasite a smear may fail to show any organisms where a few hours previously a blood examination would have shown a large percentage of infected red cells in every field of the microscope.
Pernicious Manifestations of Malaria.—These grave manifestations
arise almost exclusively in the course of malignant tertian infections.[32]
[33]
In his study of malaria Stott had about 1% of his cases
showing well-marked pernicious symptoms.

As explanations of perniciousness are given: (1) the very large number of red cells infected and destroyed by the malarial parasites; (2) the throwing off at the time of sporulation of the merocyte of a large amount of toxic material owing to the presence of such a large number of disintegrating merocytes, and (3) from the plugging of the capillaries of important internal organs by adult parasites. This may arise as the result of (a) the sporulating parasites acting as emboli, being too large to pass the lumen of the capillary; (b) from degenerative changes or distension with pigment of the endothelial cells lining the capillaries, or (c) as the result of an ovoid shape on the part of the malignant tertian parasite there is an inability to pass through capillaries which the flattened benign parasites can do by infolding (Bass), or (d) resulting from the tendency of malignant tertian parasites to agglutinate.
Types of Pernicious Malaria.—It is customary to divide pernicious malaria into the following divisions—(1) Cerebral, (2) Algid, (3) Bilious Remittent and, possibly, also (4) Pneumonic and (5) Cardiac types.
Blackwater fever is often included in the grouping but would appear to be best considered as a separate disease although almost surely brought about by malaria.
We do not understand why in one case sporulating parasites should plug the capillaries of the central nervous system, with the production of conditions resembling well-recognized nervous diseases, while in another case the damage is done the intestinal mucosa, pancreas or lungs. At any rate these pernicious manifestations of malaria should always be kept in mind when a case of sudden cerebral involvement or acute abdominal disease shows itself in a patient in a malarious country and a blood examination should be promptly made.
Cerebral Manifestations of Pernicious Malaria.—Various authorities give different clinical pictures but the more commonly accepted types are:
(1) The hyperpyrexial, when the symptoms are those of heat stroke, with a temperature going up as high as 110°F. or even higher. Such patients rapidly become comatose and as a rule die.
(2) The delirious and comatose forms are apt to be associated, the comatose condition following a delirious state. Such manifestations may or may not set in with a chill. Cases belonging to this group may arise from a typical malignant tertian infection in which the headache and restlessness have been unusually marked. The pulse is full and fast with sighing respiration, hot dry skin and flushed face. There may be rigidity of the neck muscles.
(3) Such terms as epileptiform, tetanic, aphasic, cerebellar and bulbar have been applied to malarial manifestations and are self-explanatory.
Cerebral malaria may give rise to a delusional insanity. Various psychoses or amnesia at times follow cerebral types of pernicious malaria.
Algid Manifestation of Pernicious Malaria.—In such cases we have a small thread-like pulse and a cold clammy skin. There are signs of collapse. The respiration is slow and shallow and the voice weak. It is customary to consider some of these cases, when there is vomiting and diarrhoea, with painful cramps of the legs and scanty or suppressed urine, as of choleraic type, while other cases, with blood and mucus in the stools and marked abdominal pain are termed dysenteric. Most dysenteric types only show a diarrhoea with the presence of blood.
The dysenteric type is more common but the question always arises whether the case may not have been really dysentery lighting up a latent malaria or the lowering of resistance from the malaria favoring a dysenteric infection. Stott had five algid cases of dysenteric type but not one of choleraic. The choleraic types have often been reported during outbreaks of cholera.
When epistaxis and haemorrhages from the intestines or stomach are marked features of an attack the cases are termed haemorrhagic and, if a prostrating, collapse-producing sweat be a characteristic feature, they are called diaphoretic.
Cases have been observed when the excessive sporulation was apparently taking place in the pancreas, giving the symptomatology of acute haemorrhagic pancreatitis.
Bilious Remittent Fever.—This is the most common and the least dangerous of the pernicious manifestations but tends rapidly to produce malarial cachexia. Slight jaundice and bilious vomiting may appear in the course of an ordinary malignant tertian paroxysm and only severe types, with fatal tendency, should be classed as pernicious. It sets in with marked nausea followed by bilious vomiting and bile-rich stools. Jaundice shows itself by the second day; earlier than in yellow fever, but much later than the rapidly appearing jaundice of blackwater fever. The urine shows bile pigment and a yellow foam. Epigastric distress and liver tenderness are marked features and there may even be gastric haemorrhage.
Pneumonic and Cardiac Types.—Other recognized types are when, with the symptoms of a broncho-pneumonia, we find an element of periodicity and a response to quinine—the so-called pneumonic type.
Again, usually in elevated regions, dilatation of the right heart and death have been noted as occurring in cardiac types of pernicious malaria.
Another type is one in which the sweating stage is excessive, the so-called diaphoretic type. These cases may result in collapse and such a termination may be syncopal in character.
Relapses.—Relapses are distinct features of malarial diseases, the tendency being most marked in quartan and least so in malignant tertian. A relapse after an interval of two years is very rare in malignant tertian but periods as long as nine years may intervene between attacks of quartan fever.
Relapses are intimately associated with conditions which tend to lower the body resistance, so that exposure to cold or wet or hot sun may bring on an attack. Alcoholic or venereal excesses, as well as errors of diet, may be provocative. Persons returning home from the tropics often experience relapses as they approach the cooler climate of the temperate zone. It has been well stated that the old resident of the tropics owes his condition of health rather to education than acclimatization—experience has taught him discretion.
There are three explanations of relapses of which the one supported by Ross and Bignami seems more reasonable and is that the disappearance of nonsexual parasites is only apparent and that they continue their cycle but in insufficient numbers to excite symptoms.
Parthenogenesis.—Schaudinn thought that, either spontaneously or as the result of treatment, there was a disappearance of the nonsexual forms and the male gametes, the female gametes however surviving and, eventually, through the process of parthenogenesis, producing a set of spores or merozoites which set up a nonsexual cycle. It would seem probable that Schaudinn saw red cells containing a merozoite along with a female gamete and interpreted his findings as a sporulating sexual form.
Craig thinks that as the result of the conjugation of two young schizonts a more resisting parasite is evolved, which under favorable circumstances for its development may start anew a nonsexual cycle.
Latent Malaria.—The persistence of a malarial infection, in the absence of clinical and to a great extent of laboratory manifestations, is shown by the occurrence of relapses, so that the section treating of malarial relapses applies equally to this paragraph. In addition to the factors influencing relapses, such as exposure to sun, rain and excesses of various kinds, we note a particular tendency for a latent malaria to develop activity following surgical operations and childbirth. In untreated latent cases we may have delayed healing of surgical operations.
In another paragraph there is noted the importance of examining placental smears for evidence of a latent malarial infection. Persons returning to a cool climate from the tropics, who may not have shown evidence of active malaria for months, may come down with a paroxysm upon encountering cool weather (refrigeration). Latency may be complete or there may be vague manifestations of ill health such as anorexia, malaise, irritability, headaches, anaemia and alimentary tract disturbances. Not infrequently tropical residents without symptoms may show crescents in their blood and such cases are of prime importance in connection with infection of mosquitoes. To a certain extent they are the typical carriers and should be actively treated from a standpoint of malarial prophylaxis.
Masked Malaria.—While as a rule one should not accept such a diagnosis, unless the possibility of some other explanation than malaria is excluded, yet there are manifestations, chiefly neuralgic, gastro-intestinal or in the form of varied skin eruptions which at times show periodicity and which respond to treatment with quinine.

Fig. 20.—Abnormal malaria parasites. 1, Normal red corpuscle; 2, gametocyte and schizont; 3, gametocyte and gametocyte; 4, gametocyte and schizont; 5, schizont and schizont, both undergoing schizogony. (After Dr. J. D. Thompson, “Jl. R. A. M. C.”) By permission from Manson’s Tropical Diseases.
Malarial Cachexia.—As the result of repeated attacks of any type of malaria a condition of anaemia and physical and mental incapacity may be produced. The skin has a dirty earthy hue, particularly of the face, and the sclerae show a yellowish tinging. The patient is sensitive to the slightest cold and is the victim of mental depression with deterioration of memory or at any rate lack of concentration.
There may be long periods in which the temperature is normal or subnormal but slight febrile accessions may occur from time to time and at such times the blood may show parasites.
The spleen is enlarged as may also be the liver. Twisting of the pedicle of the spleen or its rupture from even slight blows may necessitate surgical intervention.
There is anorexia and alimentary tract disturbances. A very important feature of malarial cachexia may be the occurrence of haemorrhages, particularly serious being those from the retinal vessels.
It is probable that hookworm infection has frequently been confused with the anaemia of malarial cachexia as in both of these conditions we may have a high-grade anaemia with swelling about the ankles, palpitation of the heart and shortness of breath. Some authorities have recently called attention to splenic enlargement in hookworm disease, but this is not generally accepted. There may be also[37] ascites in malaria. Urobilinuria is an important sign in malaria where other causes for red cell destruction are excluded.
The Sequelae of Malaria.—The anaemia and other manifestations of malarial cachexia have been described above. The enlarged spleen not only is a source of danger from rupture but it may cause sensations of pain or tension. The skin of those with chronic malaria tends to ulcerate from slight wounds and phagedenic lesions may occur. There may be various disorders of the nervous system varying from mental confusion or lack of mental concentration to melancholia. Neuritis and possibly peripheral neuritis may have origin in repeated attacks of malignant tertian malaria. Ulceration of the cornea is the most frequent of the ocular sequelae although even this is rare. It only occurs after many relapses. It is painful, heals slowly and tends to recur with relapses. Iritis may accompany it. Abortions are frequent unless the malaria is adequately treated.
Symptoms in Detail
General Appearance.—In the cold stage of the benign infections the face is pinched and blue to become decidedly flushed when the hot stage sets in. In malarial cachexia there is an earthy color with the pigmentation more marked about the face and knuckles. In the algid forms of pernicious malaria the skin is pale, cold and clammy, in a measure simulating cholera. Herpes labialis is very common in the benign infections, but less so in the malignant tertian ones. Jaundice is a feature of bilious remittent fever.
The Temperature.—Even in the cold stage the temperature is steadily rising and may have reached 105°F. or higher by the time of onset of the hot stage. It remains elevated during the four to six hours of the hot stage and then falls rapidly to normal during the sweating stage. The paroxysm tends to occur in the forenoon or early afternoon. In 793 typical paroxysms Stott found only 37% to occur before noon. Intermittent fever curves are characteristic of benign infections. In malignant tertian a prolonged hot stage (fifteen to thirty-six hours) is a marked feature. The onset also is more gradual and the fever tends only to remit or may remain continuous over several days, but even with such a chart there are apt to be indications of slight rises every other day.
In the hyperpyrexial form of cerebral perniciousness the temperature may rise to 112°F. and the case resemble sun stroke. In the algid forms the axillary and rectal temperatures are usually elevated.
The Circulatory System.—The pulse is small, rapid and of high tension in the cold stage to become full and bounding in the hot stage. A cardiac type of perniciousness in which the right heart dilates has been referred to.
The Alimentary Tract.—Nausea and vomiting are common manifestations of malarial paroxysms and in bilious remittent fever the bilious vomiting is an especially distressing feature.
So-called choleriform and dysenteric manifestations of perniciousness of the algid type are rarely observed.
Cases with the clinical picture of acute haemorrhagic pancreatitis have been reported as incident to excessive sporulation of malarial parasites in the capillaries of the pancreas.
The Respiratory System.—There may be a slight bronchitis in ordinary types of malarial fever. In the cerebral types of perniciousness the breathing may be markedly altered—even of Cheyne-Stokes character.

A broncho-pneumonia which shows a periodicity and responds to quinine is often considered as a pernicious type of malaria.
The Skin.—Herpes labialis is a common manifestation of benign tertian and not rarely of malignant tertian infection. Urticaria may also be noted. The skin of malarial cachexia is earthy. Of course, one must always keep in mind the skin eruptions due to quinine administered in treatment, and of these urticaria is probably the most frequent.
The Nervous System.—In both the benign and malignant infections headache is a marked feature and is accentuated during the hot stage. There may be a “flighty”[39] condition in the hot stage of benign tertian and quartan but in aestivo-autumnal infections there may be actual delirium.
Delirious and comatose states are prominent features of cerebral pernicious attacks. At times there may be an apathetic condition suggesting typhoid fever.
Almost any type of central nervous system disease may be simulated as the result of focal sporulation so that we have aphasic, epileptiform, hemiplegic, bulbar and other clinical types.
Some authors have recorded cases of multiple neuritis of malarial origin. Catto has recently examined the blood of a number of cases of multiple neuritis in Jamaica and has obtained negative malarial findings in every case. Neuralgic manifestations are features of latent malaria. Some loss of memory may be apparent after severe malaria.
The Special Senses.—Plugging of the retinal arteries may lead to blindness which may be either transient or lasting. The discs are grayish red instead of white as is the case with quinine amblyopia. The ringing in the ears is connected with the quinine treatment.
The Genito-urinary System.—In the cold stage there is apt to be frequent urination with increased secretion. Later on, there is a scanty febrile urine.
Albuminuria is rather common in aestivo-autumnal attacks and true nephritis occurs in about 2% of cases.
Plehn attaches great importance to the examination of the urine for urobilin as showing malarial infection when parasites cannot be found. The pigment particles in urinary sediment (Uriola) do not give reliable information. Bile in the urine is an important sign of bilious remittent fever.
Orchitis has been reported as a malarial complication.
The Liver and Spleen.—There is very little of importance to note in connection with the liver except tenderness and jaundice in bilious remittent fever. The spleen, however, is the organ in which centers the infection and its tenderness and enlargement are of special diagnostic value in malaria.
Even in comatose conditions pressure on the spleen may bring about indications of pain. The liability to rupture of the friable spleen of aestivo-autumnal infections is a real danger and the patient should not expose himself to injury.
The Blood Examination.—This is of prime value in the recognition of malaria, and one should examine both fresh blood preparations and stained films as well. More information is gotten from the stained films but we should also avail ourselves of the different characteristics of the 3 malarial species, which can be noted in a preparation made by taking up a small drop of exuding blood on a cover-glass and allowing it to drop on a slide and run out without any pressure on the cover-glass.
The crescents, when found, show a malignant tertian infection but there may also be present one of the benign parasites. A stained film should be used to identify malignant tertian young ring forms.
Pigmented rings are rarely observed in aestivo-autumnal fever, such parasites being caught in the capillaries as they enlarge to the stage where pigment begins to be present. Flagellated forms only develop in fresh blood preparations, 15 to 20 minutes after the taking of the blood. Of the greatest differential value is the swollen pale infected red cell of benign tertian, the normal red cell of quartan and the distorted shrunken red cell of malignant tertian.
Quinine administration may cause parasites to disappear from the peripheral circulation or it may so affect the parasite that the staining would indicate a degenerated parasite—the so-called quinine-affected parasite. It is difficult to diagnose the species of malaria from such a parasite.
Large mononuclears and transitionals containing phagocytized pigment (melaniferous leucocytes) are characteristic of malaria—the pigment however must be in the leucocyte and not free. There is a leucocytosis during the malarial paroxysm with a leucopenia and increase in the large mononuclears during the apyrexial period.
Among natives of India the large mononuclears and transitionals averaged 21% in the apyrexial stage of malaria while healthy natives rarely showed as much as a 10% count (Stott).
Some authorities have reported positive Wassermann reactions in serum of malarial patients taken during a paroxysm. All agree, however, that the serum of malarial patients at other times is negative.
Diagnosis
In the diagnosis of malaria the special points to consider are: (1) presence of malarial parasites, (2) periodicity, (3) splenic enlargement, (4) response to quinine therapy, (5) the presence of melaniferous leucocytes and (6) a high large mononuclear percentage when leucopenia is present. In the examination for parasites one should not only consider the species of parasite present but, as well, the stage of development and the presence of the sexual forms.
In an intensive investigation Bass has shown that 55.09% of those showing parasites in the blood give a clinical history of malaria while 44.91% of those with parasites in the blood fail to be associated with clinical manifestations.
Blood platelets are the findings most frequently mistaken for malarial parasites in stained blood, and the vacuoles in fresh blood. Quartan and tertian periodicity is only found in malaria, but quotidian periodicity is a feature of a host of diseases.
There are very few tropical diseases which have not been mistaken for malaria and many of these have been considered as of malarial etiology before the discovery of the real cause.
Of the cosmopolitan diseases, typhoid fever, septic conditions, including malignant endocarditis, tuberculosis, influenza, pyelitis and even syphilis are to be considered in a diagnosis of malaria.
As regards tropical diseases, kala-azar, Malta fever, liver abscess, filariasis, trypanosomiasis, leprosy, relapsing fever and yellow fever are to be thought of in differential diagnosis.
As was noted under the discussion of the pernicious manifestations of malaria, scores of diseases may be simulated by the sporulation of the malarial parasite in certain organs or areas of organs. One should always keep in mind the possibility of pain in the appendix region or in the gall bladder area as connected with malaria if in the tropics. A polynuclear increase negatives malaria and indicates appendicitis or cholecystitis. Malarial pancreatitis has been referred to before.
With malarial cachexia we must in particular keep from mistaking it for hookworm disease or other secondary anaemias due to intestinal parasites.
Provocative Measures.—Kohlbrugge’s recommendation to have patients suspected of malaria climb mountains and drink copiously of cold water, in order to bring on a relapse, is of value in the diagnosis. (Effects of fatigue and refrigeration.) It must always be borne in mind that quinine causes the parasites to disappear from the peripheral circulation. It is interesting to note that small doses of quinine given over ten days or two weeks may make a latent case active. Other provocative agents are subcutaneous injections of adrenalin (the best), or anti-typhoid inoculations. Certain physical methods, as hot and cold douches or alternating the hot air chamber at 55°C. for 10 minutes, followed by a cold bath for 3 minutes have been recommended. After injection of adrenalin the presence of parasites in the blood is at its height at the end of an hour. Sunlight is a factor in relapse.
The laboratory diagnosis of malaria has already been fully gone into in the section on etiology and that on blood examination under the heading of symptoms in detail.
The evenly spread stained film undoubtedly gives more accurate information as to species and stage of cycle than any other method. Still one should always examine a fresh specimen and if the parasites are very scarce, a thick film preparation. The thick film methods of Ross, Ruge and James are given under the chapter on the[42] blood in tropical diseases. During winter parasites tend to disappear from the circulation regardless of treatment.
Prognosis
The prognosis in benign tertian and quartan is most favorable when proper treatment is instituted, as such infections are never fatal in first attacks. Not only may malignant tertian kill in a first attack but it leads rapidly to a cachexia while the cachexia following upon benign infections is more gradual.
It is the tendency to perniciousness which makes us dread malignant tertian as we can never be sure that a paroxysm may not develop cerebral or algid manifestations and these show a very high death rate, 25 to 50%, even when promptly treated.
As regards relapses quartan is the malarial fever which is most apt to show this feature and aestivo-autumnal the least. Deaderick gives the percentage of cases showing relapses in quartan, benign tertian and aestivo-autumnal as 65, 55 and 45.
The great importance of malaria is rather its invaliding tendency and by thus reducing the powers of resistance it makes the death rate from intercurrent diseases higher. Tropical malaria does not seem to affect the native as it does the European but the high death rate of infants among the natives is undoubtedly largely connected with this disease.
Statistics vary greatly as to the percentage of fatal cases in malaria. Certain figures from tropical countries give fatal results as occurring in from 2 to 10% of cases, while statistics from temperate climates show a death rate below 1%. The mortality from pernicious types of malaria is about 25%.
Prophylaxis and Treatment
Prophylaxis.—There are three methods in the prevention of malaria, all of which may be combined, as was the case in the Canal Zone region of Panama. These are: (1) Destruction of anopheline mosquitoes; (2) protection of the individual from the bites of mosquitoes, and (3) quinine prophylaxis.
It may be stated that it is frequently advisable to carry on the mosquito warfare without regard to the question of the kind of mosquitoes destroyed. In general terms the malarial mosquito breeds in the suburbs of towns or in districts more distinctly rural, while the transmitter of the more dreaded yellow fever, prefers breeding places in the immediate vicinity of city houses.
Bentley has recently noted that, with improvement in agricultural methods and utilization of marshy lands, malaria tends to disappear as much from the physical improvement and thereby greater resistance of the people as from the destruction[43] of mosquitoes by the draining of the swamps. The resulting greater prosperity makes better food and shelter obtainable.
1. Destruction of Mosquitoes.
Such measures may be directed either toward the larva or fully developed insect.
(a) Measures against larvae. When practicable permanent measures should be preferred to temporary ones and when agricultural development goes along with drainage of swamps the cost is repaid.
The doing away with mosquito breeding places may be accomplished by filling in pools or by making ditches with smooth sloping sides to carry away the water. These ditches require a great deal of attention to prevent their filling up with tropical vegetation and thereby adding to breeding places. Subsoil drainage with tiled drains is better. Care should be exercised that public works operations do not raise the level of the subsoil water.
Anophelines tend to breed in sluggishly moving streams or in stagnant pools especially where there is a luxuriant growth of weeds or grass, and are not apt to be found in rapidly flowing streams, hence the necessity for constant care of ditches and the like to prevent their becoming obstructed by vegetation or silt. When filling in or drainage is not practicable the method of oiling the surface of the pool with crude petroleum is to be recommended. One uses about ½ pint for every 100 square feet of surface and the process should be repeated every two weeks.
In places where oil is not effective, Barber recommends Paris green mixed with dust and so used as to form a scant surface deposit. Anopheline larvae, being surface feeders, ingest it and are killed. It does not affect Culex larvae. On account of its ease of transportation, and adaptability to weedy places where oil does not penetrate, Paris green dust will doubtless prove a valuable selective larvicide. Mayne and Jackson recommend cresol as the best larvicide. In 1 to 1,000,000 parts it is an effective larvicide, and even in 1 to 1,000,000,000 it is destructive to young larvae.
Mixtures of soft soap and petroleum are better than petroleum alone.
Winds are apt to blow away the surface coating of oil and it is difficult to oil the surface of a pool filled with grass. Wise recommends crude carbolic acid, using 1 ounce to 16 cubic feet of water.
In using any larvicide it is well to introduce it along the banks of water collections with a long-spout can and mix it thoroughly with a stiff reed broom.
There are many enemies of mosquito larvae, such as tadpoles, water-beetle larvae and various small fish such as “millions.”
Terni suggests the using of such fish as carp and tench which have a food value as well as a larvicidal one.
(b) Measures against the mosquito. The clearing away of grass and brush from around houses exposes the mosquitoes to the sun in which they cannot live long.
When inside the house they may be destroyed by sulphur fumigation, 1 or 2 pounds of sulphur for each 1000 cubic feet and with an exposure of two hours.
It is usually stated that mosquitoes may hibernate during winter following infection in the autumn and that cases of malaria in early Spring may be explained by their bites. Examination of hibernating mosquitoes for zygotes does not give strong proof to this view but such mosquitoes, becoming active with a rise in temperature, may bite gamete carriers in the house and thus spread malaria.
Pyrethrum powder, which is set on fire with a little alcohol, may be burned, using 2 pounds per 1000 cubic feet, and an exposure of four hours. This does not certainly kill the insect and the stupified mosquitoes should be swept up and burned.
Giemsa’s spray is now considered an excellent measure for killing mosquitoes in rooms. The composition is as follows: Pyrethrum tincture (20 parts powdered pyrethrum blossoms to 100 parts alcohol), 480 grams; odorless potash soap, 180 grams; glycerine, 240 grams. Before using it dilute with 20 times its own weight of water, and spray the walls of the room with a spray pump.
The use of a small square of wire gauze on a handle (fly swatter) to kill mosquitoes as they rest on a wall is of great value in keeping them down in a screened house.
2. Protection of the Individual.
The house should be thoroughly screened with copper-wire screens which should have 18 meshes to the inch. Mosquitoes can pass through a 15 mesh screen. Screen doors should always open outward and close automatically with spring hinges.
It is almost impossible to screen a ship’s hatches effectually. Then too the screening of fan intakes and ports interferes with free circulation of air, thus adding to the discomfort of the heat of the tropics.
As malarial mosquitoes bite chiefly toward evening one should not expose himself after sunset.
Houses should be far removed from native habitations.
Mosquitoes prefer the lower floors of a house so that the upper stories are preferable for sleeping.
Mosquito nets at night, with protection by veils for the face or coverings for the hands and ankles, when going out of the house, are well-known measures.
It is stated that Emin Pascha always carried a mosquito net and never suffered from malaria. He thought that the cause of malaria was too large to go through the net.
Even when mosquito nets are intact and well tucked in there is the weak point that a person sleeping on a narrow cot is apt to put his arm or leg against the net, in which case the mosquitoes readily bite the skin presenting at the open spaces.
Oil of citronella is often used to keep away mosquitoes.
Brooks recommends Neal’s method. In this daub a solution of 1 ounce Epsom salts in 10 ounces of water on the exposed parts and allow to dry.
Application of certain pine products used as mange cures will keep away mosquitoes.
3. Quinine Prophylaxis.
The ease of application of quinine prophylaxis, as compared with the more permanent methods of mosquito destruction and screening, appeals to the sanitarian, especially in the tropics.
It is just as easy to give quinine to a man in the tropics as it is in temperate climates, but when one considers the propositions of draining tropical swamps and shutting off circulation of air on a torrid night with fine wire gauze in the windows and closely woven mosquito nets around the bed, the question is decidedly different. In consequence, the tendency is for the average man to despair of accomplishing anything in the way of mosquito destruction and screening and to seize eagerly on the inferior alternative, that of quinine prophylaxis.
Ronald Ross presents this matter concisely and to the point when he states that it is not a good policy to substitute a measure which does not exclude infection, but is merely extirpative in some cases, for positive prevention. From this it will be seen that unless it is clearly recognized that quinine prophylaxis may in some cases extirpate, but does not prevent, there might be a tendency to adopt this measure and neglect the two proper ones.
As regards the relative merits of quinine prophylaxis and protection from mosquitoes Celli gives the following figures:
| Treatment | Infected | |
| Mosquito protection plus quinine prophylaxis | 1.76 | % |
| Mosquito protection alone | 2.5 | % |
| Quinine prophylaxis alone | 20.0 | % |
| No protection at all | 33.0 | % |
With quinine prophylaxis, there is the possibility of producing an immunity to quinine on the part of the parasites which have been introduced by infected mosquitoes and held in check by the prophylactic but not curative dose of quinine. Later on when the quinine prophylaxis is discontinued the parasites begin to multiply vigorously and seem to possess an immunity to quinine.
As an instance of this, 398 marines served in 1906 for about one month on the Isthmus of Panama during which time they were given 9 grains of quinine daily as a prophylactic.
During this month there was only an occasional case of malaria among the men. At the end of the month 298 of the original 398 returned aboard ship and sailed for the North. Two days later 20 cases of malaria developed, followed the next day by 53 and the day following that by 45. The medical officer then resumed 10-grain prophylactic doses for those not down with malaria but notwithstanding this there were 215 acute malarial paroxysms, some of them of pernicious type, among the 298 men.
It was noted that these men did not respond satisfactorily to quinine treatment even when the drug was administered intramuscularly.
Of the greatest value have been the observations of Stott. Using native Indian troops he gave one group (3931) prophylactic quinine while the other (3906) did not take quinine prophylactically. He continued this experiment one year giving 15 grains 3 times weekly for five months, and 10 grains 3 times weekly for the remaining seven months. Those taking quinine gave 170 primary admissions while those not taking it gave 179 (43.2 per thousand strength for the former as against 45.8 per thousand for those not taking quinine prophylaxis). Further observations were that those taking quinine prophylaxis showed a greater tendency to relapse, had somewhat longer fever, and required more quinine for treatment.
Linnell states that he used quinine prophylaxis among 2000 coolies for a year, giving 5 grains or more daily with most discouraging results. It seemed to act as a slow poison and did not protect.
Quinine Immunity.—Bignami thinks that malarial relapses may be connected with insufficient initial treatment so that quinine-resisting forms survive and later, when some factor lowers the patient’s resistance, active multiplication of parasites, which are not readily destroyed by quinine, follows.
While quinine prophylaxis may not be desirable on board ship, where one is in a position to readily recognize and treat the onset of malaria and to more or less efficiently carry out mosquito protection methods, or in a wealthy seaport, where sufficient interest in and funds for draining and screening exist, yet on military expeditions or exploring trips in tropical or subtropical countries it is the only practical method of keeping a force efficient.
Of course, one should also utilize mosquito nets as assisting in protection from malaria, and as effective for yellow fever, dengue and filariasis.
Methods of Prophylaxis.—There are innumerable methods of carrying out quinine prophylaxis among which may be noted.
(a) Celli’s method. In this there is given 3 grains of quinine each morning and 3 grains each night. Taken in this way Celli thinks that harmful effects from quinine are avoided, that quinine immunity does not occur and that there is no danger from quinine haemoglobinuria. For children he recommends the tannate in chocolate tablets.
(b) In 1909 Bertrand and other members of a French Commission recommended two consecutive doses of 5 to 10 grains every seventh and eighth day for benign infections and two consecutive prophylactic doses of 10 to 15 grains every third and fourth days where malignant tertian was prevalent.
(c) Ziemann gives 15 grains every fourth day with the idea that the quinine is entirely eliminated in four days. Nocht gives about 12 grains on two succeeding[47] days of each week in divided doses of 2 or 3 grains instead of the entire amount in one dose.
Koch gave 15 grains on tenth and eleventh days.
(d) Castellani’s method of 5 grains daily and a double dose once a week is the one I recommend.
Sterilization of Carriers.—In addition to quinine prophylaxis for those not infected we also have quinine disinfection for native or other carriers of malaria. For these infected persons Koch recommends 15 grains on two to three successive days of each week, the course to be continued for three months. This plan of extirpation of the parasites of malarial carriers is of great practical application. Gill uses 10 grains of quinine daily for six months after discharge from hospital. The effect of tartar emetic on malarial gametes may prove of value.
Treatment.—Cinchona bark was first introduced into Europe in 1640 and has its name from Countess Chinchon, wife of the Peruvian Viceroy, who was cured of a fever by this bark in 1638.
Much of our knowledge of the therapeutics of cinchona bark is due to Torti. In giving the drug he used a large dose the first day and the same for the subsequent two days. After that he administered smaller doses for a week and then still smaller doses for two or three weeks. Quinine was not introduced until 1820.
At present quinine or some salt of the alkaloid is used in malaria instead of preparations of cinchona bark.
Toxic Effects of Quinine.—The most important untoward manifestations of cinchonism are the very common scarlatiniform, eczematous or urticarial rashes, gastric disturbances and vertigo. Impairment of vision may be brought about by quinine and quinine haemoglobinuria is a recognized possibility. In quinine amblyopia the pupils do not react to light and the optic disc is very pale, thus distinguishing the impairment of vision due to the plugging of the retinal vessels by the malarial parasite, in which condition the pupils do react to light and the disc is a grayish red.
Quinine Idiosyncrasy.—Fortunately the taking of quinine is well borne by the great majority of persons but in exceptional cases we may have developing, even after doses as small as one grain, of (a) severe nausea vomiting or diarrhoea, (b) various skin eruptions, usually of a scarlatiniform or urticarial type, (c) marked ringing in the ears, dizziness or deafness, (d) impairment of vision, (e) dyspnoea and (f) malarial haemoglobinuria. To determine an idiosyncrasy make a scratch on the flexor surface of the forearm and apply a drop of a 1 to 10 solution of quinine. Oedema with a wide zone of erythema in about 5 minutes shows idiosyncrasy. A control with normal saline should be made. It is well to make this skin test before giving quinine intravenously. For desensitization we give 1/10 grain of quinine combined with 5 grains of bicarbonate of soda and in about 1½ hours we give 1 grain with 5 grains of bicarbonate of soda.
The cheapest and most generally obtainable salt is the sulphate. It is soluble in 720 parts of water and contains 74% of alkaloid. The opinion now prevails that this is one of the less desirable of forms for the administration of quinine. It is frequently obtained in pill or tablet form and it must not be forgotten that such preparations may be almost stone-like and pass through the alimentary tract without absorption. If used it is best to give it in acid solution made by dissolving 5 grains of quinine sulphate in one teaspoonful (1 dram) of water with one drop of concentrated hydrochloric acid.
Dosage of Quinine.—The ordinary full dose of quinine for an adult is 10 grains repeated three times in a day or 30 grains daily. Some authorities recommend 15 grains three times daily (45 grains) at the commencement of treatment and such dosage seems to be just as efficient as the larger dose of 60 grains in a day. In cinchonism we have ringing in the ears, fullness in the head, deafness and dizziness. For children Bass recommends 1/20 of the adult dose for each year of age so that a child of 5 years age would receive ¼ of the adult dose. Beyond 15 years of age the dose is that of an adult.
There now seems to be a tendency to use the alkaloid itself instead of its salts, it having been found that the alkaloid and its very insoluble tannate are absorbed from the digestive tract equally as well as the soluble salts. Quinine is almost insoluble in water (1-1560) and hence has less bitter taste than the soluble salts. It is also less haemolytic so that it may be used with greater safety where blackwater fever is feared.
Euquinine or ethylcarbonate of quinine contains 81% quinine, and is only soluble in 1-12,000 parts of water, hence its comparative tastelessness. It is expensive.
Quinine tannate contains only about 30% of quinine and is practically insoluble in water. It is often given to children in chocolate tablet form. It can often be taken by those who suffer disagreeable effects from other salts. The dose should be 2½ times that of quinine sulphate.
Until recently the bimuriate (72% of alkaloid and soluble in 1 part of water) or the chlorhydrosulphate (74% of alkaloid and soluble in 2 parts of water) have been considered the most desirable salts for hypodermic injections or oral administration. At present, owing to its extensive use in local anaesthesia and incident availability, bimuriate of quinine and urea is to be recommended for intramuscular use. It contains 60% of quinine and is soluble in an equal amount of water.
It has been found to have a slightly greater tendency to produce amblyopia than other quinine salts and should not be used intravenously.
In a very important series of experiments on prisoners, MacGilchrist found that hydroquinine (a synthetic product of quinine) was about 20% more efficient than quinine. Cinchonine was about the same as quinine while quinidine was about one-half as potent as quinine.
Acton has praised the value of cinchona febrifuge (the combined alkaloids of cinchona) given in daily doses of 21 grains for ten days.
Methods of Administration
By Mouth.—This is the usual method and is the one to be preferred in all cases where other methods of administration are not necessitated.
Golgi believes that quinine is most effective at the time of liberation of merozoites from the bursting merocytes, hence he administered quinine four hours before the attack with a view to having it in its greatest concentration in the blood at such times. When given intravenously the full concentration is obtained in a very few minutes but with other methods this is a matter of great variation.
It is usual to give the quinine in capsules or cachets, the pills and tablets being often so hard that they do not dissolve in the alimentary tract.
The method usually in vogue in military services is to give quinine sulphate in acid solution. This method is trying to the stomach.
By Subcutaneous Injections.—This method is liable to be followed by necrosis and abscess formation or fibrous indurations. Quinine and urea hydrochloride is preferable either for subcutaneous or intramuscular injection.
Cohen holds that quinine and urea hydrochloride controls malarial infection more rapidly and efficaciously than any other salt of quinine when given intramuscularly. In order to prevent tetanus or other infections he is very careful about asepsis. He recommends that a 10 to 15-grain dose be injected every day for a week, then once a week for a month, then once every two weeks for another month. He considers a 33% solution as best, thus one could give 10 grains in the contents of an all-glass 2 cc. syringe.
James has recommended very dilute solutions for subcutaneous injections (1-150). There are practical objections to this method. It is usual to give about 1 gram (15 grains) of a soluble salt in 10 cc. of water. The present view is that subcutaneous injections deserve condemnation.
Intramuscular Injections.—It is now recognized that when quinine is not well borne when given by mouth the two modes of administration to be followed are either by intramuscular injection or introduction of the drug into a vein. For intramuscular use we dissolve a soluble salt of quinine, as the bimuriate or chlorhydrosulphate, in distilled water or sterile saline. A 50% solution is commonly used and from 6 to 10 grains of quinine is injected into the gluteal muscles of one side about 3 inches below the iliac crest. Repeat the injection on the other side. Repeat this daily dose of 12 to 20 grains for 3 or 4 days; then give quinine by mouth.
The solution should be autoclaved before use and the skin at the site of injection painted with iodine. Dudgeon has called attention to the constant production of oedema and necrosis in the area of the injection. This tissue necrosis occurs immediately and persists for a long time. If the injection is made in the neighborhood of an important nerve, neuritis may ensue. Repeated injections should not be given in the same area.
Of course in the use of quinine salts through the medium of the hypodermic needle everything must be sterile.
Intravenous Injections.—Bass and many others think that when quinine cannot be administered by mouth it should be given intravenously. Not only is there the objection of inflammatory reactions or necrosis when the drug is given subcutaneously or intramuscularly but the absorption of the drug is so slow that the patient may die before we obtain the desired effect. Ross condemns the subcutaneous method and recognizes the advantages of the intravenous method over the intramuscular one when rapidity of action is desirable.
In giving quinine intravenously Bass thinks that 10 grains at one time is sufficient and that a 20-grain dose is not without danger.
He does not think it necessary to give more than 30 grains daily in this way. Intravenous quinine seems to be entirely eliminated within twenty-four hours and most of it within twelve hours.
When used in cerebral malaria he repeats the 10 grains intravenously in eight hours if the drug cannot then be given by mouth. Bass thinks that theoretically amyl nitrite might relax the cerebral capillaries which are obstructed by parasite-infected red cells and thus enable the quinine in the circulation to reach such cells.
The best known method of administering quinine intravenously is that of Bacelli. In this method 1 gram (15 grains) of a soluble salt of quinine is given in 10 cc. of water.
MacGilchrist has shown experimentally that such a strength of quinine (1-10) will coagulate blood serum.
In my opinion this is a dangerous method if the injection is made rapidly. There is no doubt as to the necessity for using the intravenous channel in cerebral or algid types of perniciousness when intramuscular injections do not give results. The generally accepted method is to use a salvarsan technique with a dilute solution of quinine, giving 1 gram (15 grains) of some soluble salt of quinine in 250 cc. salt solution. Such injections should be given cautiously. Quinine hydrochloride, which is soluble in 40 parts of water, is the salt usually recommended. MacGilchrist considers the very soluble acid salts as haemolytic and prefers to give quinine base—3 pints of a solution of the alkaloid, containing about 12 grains.
McLean has used concentrated solutions of quinine intravenously several hundred times in cases of malaria (6 being blackwater fever ones) without any untoward results. He autoclaves his 10-grain solution[51] of hydrochlor-sulphate in 10 cc. of sterile water for twenty minutes at 15 pounds, and injects it slowly into an arm vein, allowing about two minutes for the injection. The patients complain of a slight cough and hot feeling in the lungs with a succeeding dizziness which rapidly disappears. He is opposed to intramuscular injections and found intravenous ones diluted 1 to 250 often to cause shock and collapse.
Rectal Administration.—Some authorities recommend the administration per rectum of a soluble salt of quinine in about 3 times the usual dose by mouth or hypodermically. It is considered applicable in cases where there is marked vomiting. It certainly is the least satisfactory way of giving quinine.
Dosage and Length of Treatment.—In Panama the standard preliminary treatment is to give from 3 to 5 grains of calomel followed by 1 or 2 ounces of 50% magnesium sulphate.
Fayrer holds that a torpid liver interferes with the efficient action of quinine, hence the value of calomel and salts. I prefer to give 2 or 3 grains of calomel, in divided doses, followed by sodium phosphate, 2 drams, every two hours, for three or four doses.
Standard Method.—The National Malaria Committee of the United States recommends the following treatment: Give 30 grains of quinine daily in three 10-grain doses. Keep this up for 4 days and follow by 10 grains every night for 8 weeks. Where the infection does not present acute symptoms give the 10 grains daily for 8 weeks.
Canal Zone Treatment.—So soon as the diagnosis is made give 15 grains of quinine 3 times daily (45 grains in twenty-four hours) and continue such treatment for a week or until the temperature has been normal for five or six days. Then give 10 grains 3 times daily for ten or twelve days.
It is considered that by employing such thorough treatment from the beginning the tendency to latency or relapse is prevented—in other words the disease is really cured. It is interesting to note that Torti recommended large single doses at the commencement of treatment.
Espach has noted that he had frequent relapses in many cases treated by this method. In my opinion the Canal Zone treatment should be followed by 10 grain doses daily for 8 weeks.
Tonics of iron, arsenic and strychnine are valuable in treating the anaemia, but it is not advisable to add small doses of quinine to such tonic mixture.
Repeated Small Doses.—In Nocht’s method we give the quinine in small doses repeated several times in the day, as 3 or 4 grains given 5 or 6 times daily. Such[52] treatment is thought advisable when there is a tendency to haemoglobinuria or when giving quinine to pregnant women.
In giving the small doses one should see that they are given during the night as well as the day.
Quinine and Pregnancy.—There is frequently hesitancy in giving quinine to a pregnant woman but unless the malaria is controlled the patient will be apt to abort. Potassium bromide is thought to control the ecbolic influences of quinine.
Clark states that the experience at Ancon Hospital would indicate that quinine can be given with impunity to pregnant women. In malarial subjects quinine after parturition is of value not only in controlling a fever due to malaria but it also favors involution and aids in the healing of perineal tears. The quinine also is beneficial in improving the quality of the mother’s milk and does no harm to the child.
Manson’s Method.—In a benign malarial infection Manson prefers to wait until the hot stage has been passed and the patient is beginning to perspire, this idea being that the headache and other symptoms are aggravated and that very little advantage is gained by treatment during the early part of the paroxysm. He gives 10 grains at the onset of the sweating stage and afterward 5 grains, 3 or 4 times daily, for the following week. He then gives a daily tonic containing arsenic and iron, with a quinine treatment every seventh day for about two months.
For regularity he advises the quinine treatment on Sunday giving a dose of salts in the morning followed by three 5-grain doses during the day.
Manson notes the danger of large doses of quinine as producing not only serious disturbances of sight and hearing but pronounced cardiac depression as well.
There are many who speak highly of Warburg’s tincture in treatment. It is both laxative and sudorific. The dose is ½ ounce (15 cc.) which contains about 5 grains of quinine sulphate and 4 grains of extract of aloes. As a rule it is better to give the quinine and the laxative separately.
More recently the tendency has been to give large doses of quinine, not only for its greater curative value but, as well, for the prevention of relapses. Craig, however, states that in his experience with aestivo-autumnal infections he has yet to see a single case, in which treatment was promptly instituted, that did not recover with a daily treatment of 30 grains.
Koch’s Method.—Koch recommended 15 grains each day for a week, then three days without quinine. Then three days with 15-grain doses each day. Then one week without quinine, followed by three days of treatment. This plan of a weekly interval followed by three days of treatment is continued until not fewer than 30 15-grain doses are given over nine or ten weeks.
Drugs Other than Quinine.—Salvarsan and neosalvarsan have been extensively used and with some success in benign infections but without material effect in malignant tertian ones.
Intermittent Treatment.—There are those who consider a treatment in which days of quinine administration are followed by days without quinine as equally efficient and less trying on the patient. Some of the experiences of Stephens and his colleagues indicated that 45 grains on two consecutive days of each week and continued for 8 weeks gave better results than 30 grains daily over such a period. In their experiments a dosage above 45 grains in a day did not seem any more efficient than 45 grains, so that this may well be considered as a maximum dose. On the whole however there seems to be a greater tendency to relapse following an intermittent treatment and Acton, as a result of his comparison of intermittent and continuous methods, deprecates the intermittent one.
Some have thought that salvarsan aided the specific action of quinine.
Many physicians recommend arsenic in the form of Fowler’s solution or as sodium cacodylate. It is most useful in chronic cases. Some preparation of iron is, of course, indicated in malarial anaemias.
It has been claimed that radium and X-ray treatment, when directed to the spleen, assist the action of quinine.
Methylene blue, next to quinine, has been considered as the most valuable drug. It is given in 2-grain doses every four hours. It is also given intravenously.
The form of methylene blue to use is that labelled “Medicinal.”
It is often stated that the opium fiends of the tropics are immune to malaria and some physicians have claimed antiperiodic properties for the drug. Dover’s powder is lauded by some as of value in symptomatic treatment.
Surveyor has recommended picric acid in the treatment of malaria in doses of 2 grains two or three times daily.
Recently hectine, a remedy somewhat similar to the cacodylates, has been strongly recommended by the French. It is given intramuscularly in 2-grain doses. It is said to be valuable when there is a leucopenia as it has a tonic action. It has been recommended to combine this treatment with quinine.
It is said to be a good substitute for quinine in blackwater fever.
Rogers has recently noted the value of tartar emetic injections in eradicating the sexual parasites of carriers.
After rather extended trial of this drug for the above purpose and as a method of treating ordinary infections the general opinion is against its value.
General and Symptomatic Treatment.—During the course of the fever the patient should remain in bed and given only broths. In the intermissions of the benign[54] forms one may allow a more generous diet. It is important that the patient be not allowed to become constipated and as a laxative one grain of calomel in divided doses followed by effervescing phosphate of soda is very satisfactory.
For the nausea sips of an ice-cold alkaline mineral water or cracked ice will generally prove effective. In more refractory cases spirits of chloroform or even a hypodermic of morphine may be necessary. Counterirritation to the epigastrium is often a help. Phenacetine may be given for the headache although ice water compresses are generally sufficient. In algid states hot water bottles should be applied to the body. During convalescence excesses in food or drink should be avoided as well as fatigue or exposure to wet or cold.
CHAPTER II
BLACKWATER FEVER
Definition and Synonyms
Definition.—Blackwater fever is a disease of disputed etiology but recently there has seemed to be rather general agreement that it is connected with repeated attacks of malaria. It is prone to affect the old European residents of parts of the tropics where malignant tertian is rampant.
On the basis of lowered integrity of the red cells, by reason of repeated attacks of malaria, we may have extensive lysis of the red cells following the administration of a dose of quinine or as the result of refrigeration, excessive exposure to the sun or great fatigue.
Clinically we have a prostrating chill of asthenic type associated with early jaundice and the passage of porter-colored urine—haemoglobinuria.
Synonyms.—Haemoglobinuric Fever, Bilious Haemoglobinuric Fever, Haemorrhagic Malarial Fever.
French: Fièvre Bilieuse Hemoglobinurique. German: Schwarzwasserfieber.
History and Geographical Distribution
History.—There is no reasonable doubt that the explanation of the fact that blackwater fever was first brought to the attention of the medical world, by Lebeau and other French naval surgeons, in Madagascar, in 1850-1853, was due to the confusion of this disease with the bilious remittent type of pernicious malaria as well as with yellow fever. Even after the clinical picture was well recognized, disputes as to the nature of the coloring matter of the characteristic urine were frequent, some considering that the dark color, which we now know to be due to haemoglobinuria, was due to haematuria or that the color was due to bile. Blackwater fever must have been the condition referred to in medical literature of the period, 1850 to 1870, under the names “Fièvre bilieuse haematurique,” “haemorrhagic malarial fever” and “febris remittens haemorrhagica.”
It was first described in the U. S. by Cummings of Louisiana in 1859. Other American physicians during the next ten years, described the disease from various other Southern states.
Veretas noted the presence of the disease in Greece, in 1858.
It is rather remarkable that the disease was not noted by so keen an observer as Torti, if it existed in his time, and Manson states that it is strange that it should not have been recognized in India if it had existed there prior to recent times. Some think that its introduction into Africa has been of recent occurrence. There are two explanations of the recent greater prominence of the disease in Africa and other tropical areas, where malignant malaria prevails extensively, which are (1) that there has been a great influx of susceptible Europeans into such areas during the past twenty or thirty years and (2) that the more frequent and excessive dosing of malarial patients with quinine is responsible.

Geographical Distribution.—It is in tropical Africa that the disease is of prime importance as a cause of death and invaliding. Here it prevails chiefly in West, Central and East Africa from about 12° N. to 12° S. latitude. It is less frequent in Northern Africa although a considerable number of cases have been reported from Algeria. It is unknown in Egypt, a country where malaria is very rare in Europeans.
In India it occurs in several districts and Stephens states that in the Duars (Bengal) he saw more cases in a fortnight than he had seen in the same time in Africa. In Europe it occurs chiefly in Southern Italy, Sicily, Sardinia and Greece. Blackwater fever was frequently noted among the British forces in Macedonia and Palestine during the World War.
It is common in Central America and Northern South America, especially in the regions of the Amazon basin, in Brazil.
In the U. S. it is chiefly found in the most malarious sections of Arkansas, Mississippi, Louisiana, Texas, Alabama, Georgia, Florida and South Carolina. It would seem that it is becoming more rare in the Southern States.
As a result of malarial prophylaxis among the Americans working in the Panama Canal Zone it has almost disappeared among them although still common among[57] the white Europeans in the same region who neglect quinine prophylaxis and mosquito protection.
Etiology and Epidemiology
Etiology.—There seem to be cases where from very heavy infection with the malignant tertian parasite, as from 12 to 20% of the red cells, one can expect the appearance of a more or less dark urine, the color of which is due to haemoglobinuria. Such cases give support to the old view that haemoglobinuric fever was simply a type of pernicious malaria.
Brem has proposed for such cases the designation, pernicious malarial fever with haemoglobinuria.
The idea as to etiology which now seems most generally accepted is that blackwater fever occurs almost solely in those who have resided for considerable periods of time in districts where malignant tertian malaria is very prevalent and intense and who have repeatedly suffered from such malarial attacks. Rarely blackwater fever may be connected with benign tertian infections or exceptionally with quartan ones. As a result of the damage done the patient by the malarial attacks there is a tendency on the part of his red cells to haemolysis which may be due to the production of a hypothetical autolysin or to anaphylactic sensitizations, as has been suggested recently.
Malaria is the predisposing cause and the exciting cause may be any of a number of different factors capable of lowering body resistance such as the occurrence of another malarial attack, the administration of quinine, particularly of the acid salts of quinine in rather large doses, refrigeration, as brought about by one’s clothes becoming wet and then later subjected to the chilling influence of a sea breeze, to excessive fatigue or dietetic or alcoholic excesses.
Quinine administration, particularly if associated with refrigeration, is the most common exciting factor.
As regards the association of malaria and blackwater fever Stephens, in a study of 390 cases of blackwater, found that 73% of the cases showed malarial parasites on the day preceding the haemoglobinuria, 47.5% on the day of the attack and 23% on the day following the appearance of the dark urine. Other workers give higher figures as 95, 70 and 20%.
Where one utilizes the methods of examining for increased percentage of large mononuclears or for melaniferous leucocytes, in those cases not showing malarial parasites, the percentage of evidence of malaria is greatly increased. It is necessary to understand that a small percentage of cases diagnosed as blackwater fever do not show evidences of malaria at autopsy and cases are recorded where blackwater has attacked persons who had never had malarial fever, such instances, however being exceptional.
The Quinine Theory.—This idea as to the causation of blackwater fever first originated with Veretas, in Greece, in 1858. Later Tomaselli supported this view in Italy and more recently it was advocated by Koch. Just as in connection with the influence of Koch’s great prestige much harm was done in prophylaxis against bovine tuberculosis so in this matter of quinine in the causing of blackwater the influence was unfortunate because many persons with severe malaria now refuse to take the specific quinine for fear of bringing on haemoglobinuria.
It may be stated that quinine alone, even in doses which are capable of producing profound toxic effects such as disturbances of sight and hearing, weak heart and collapse does not, other than exceptionally, cause haemoglobinuria. It has even been stated that quinine base and quinine tannate tend to prevent haemolysis, haemoglobinaemia and haemoglobinuria. Blackwater fever may develop without the previous administration of quinine.
Theory as to Acidosis with a Damaged Liver Plus Malaria and Acid Salts of Quinine.
MacGilchrist has recently advanced the idea that blackwater fever is brought about by an acidosis in one with a damaged liver plus malaria and the administration of acid salts of quinine. He thinks that one can safely give the quinine when alkalis are being given and that quinine base is protective against haemolysis.
Theory as to Its being Caused by a Piroplasm.
Sambon has thought by reason of the clinical resemblance of blackwater to certain haemoglobinuric diseases in cattle, dogs and sheep that such a cause might be operative. These parasites of the red cells are easily discernible in the animal infections but have never been seen in blackwater fever.
The Chlamydozoal Hypothesis.
Leishman has recently noted appearances in the large mononuclear cells of the blood of blackwater patients of certain cell inclusions which he thought to be of chlamydozoal nature and that these chlamydozoa might be etiological factors. Such appearances may not only be absent in marked cases of blackwater but may be seen in conditions other than blackwater fever.
Epidemiology.—There seems to be a consensus of opinion that when malaria is kept in check by proper and persistent quinine prophylaxis or by other antimalarial measures blackwater fever becomes mild in character or even nonexistent. It is those who are careless about quinine prophylaxis or those who expose themselves to depressing influences as cold, wet, excessive fatigue or alcoholic debauches in whom blackwater shows itself.
Overexertion leading to fatigue and chilling seem to be the most common exciting factors. Those in bad health from disease or lack of proper diet seem more susceptible. A peculiar feature of the disease is that it may not be present in a district for a number of years and then assume almost epidemic proportions. Europeans are usually exempt from attacks during their first year in endemic tropical areas. Dudgeon obtained a malarial history in every one of a hundred cases observed by him in the Balkans.
Pathology and Morbid Anatomy
As a result of the excessive destruction of red cells the liver cannot convert the great amount of haemoglobin outpouring into bile pigment so that haemoglobinaemia and haemoglobinuria result. It has been estimated by Ponfick that if ⅙ of the red cells are destroyed the liver is unable to dispose of the liberated haemoglobin and haemoglobinuria results. A damaged liver would be less competent. Various discussions as to autolysins and complement content of serum have arisen.
Dudgeon has demonstrated active haemolysins in the tissues and urine of blackwater fever cases which bodies he was unable to note in other conditions including malaria. There was no evidence of increased fragility of the red cells. There was no evidence of auto-haemolysis. Bile pigment in the plasma occurred in most of the cases which ended fatally.
As a rule we have the pathological findings which go with malaria. As peculiarities of blackwater noted by Whipple and others may be mentioned congestion of the kidneys with purple-colored pyramids. In the spleen the Malpighian bodies are prominent and sharply outlined. Very striking are the necroses of the Malpighian corpuscles of the spleen and focal necroses of the liver. Whipple considers that this speaks for a powerful circulating toxin in blackwater fever which is not present in malaria.
The liver cells in the area of the central veins show the most marked destruction. The myocardium shows fatty change and the fat lipoid content of the adrenal is reduced.
The anuria is thought to be mechanical and due to the plugging up of the tubules by haemoglobin casts.
The urine shows a reddish to black color and has a sediment made up of granular débris with haematoidin crystals and only rarely a red cell. It is not a haematuria.
The absorption bands of methaemoglobin are usually noted spectroscopically.
Urobilin and albumin are present in large quantities.
Symptomatology
A Typical Case.—In a person who has lived in an intensely malarious region for one or two years or even long after he has left such districts and who has had several malarial attacks, there comes on what is considered as another malarial chill, which may or may not definitely be connected with some resistance-lowering influence, as exposure to tropical[60] sun or rain, or indulgence in dietary or other excesses, or following in one to six hours the accustomed dose of quinine. This chill, however, is more prostrating than those formerly experienced and upon passing his urine the patient notes its reddish to black coffee color and himself makes the diagnosis of blackwater fever. The attack comes on suddenly with a very severe chill, marked prostration and pain over the region of the kidneys. The temperature in a typical case rapidly goes up to 104° to 105°F.
Rather profuse sweating accompanies the fall of the fever and the patient is markedly debilitated after the subsidence of the fever. There may be a recurrence of the paroxysm the following day. The fever course, however, may be more or less continuous or remittent. In other words it tends to be irregular and atypical.
Nausea and bilious vomiting come on early with epigastric distress. Almost as pathognomonic as the haemoglobinuria is the early and intense jaundice. This comes on within a few hours or almost simultaneously with the haemoglobinuria and usually lasts for two or three days after the haemoglobinuria and fever have ceased. Itching of the skin of this jaundice is not noticeable.
The spleen and liver are enlarged and tender. Albuminuria comes on with the haemoglobinuria and shows from 1/10 to 4/10 of 1% of albumen by weight.
The pulse is rapid, 110 to 120, from the first but soon becomes feeble and of low tension. In severe cases the very rapid almost thready pulse, with pallor and cold extremities, may resemble a severe haemorrhage. Epistaxis is not uncommon. A very unfavorable symptom seems to be hiccough. Another frequent cause of death and the one against which we chiefly direct our therapeutic measures is anuria with subsequent uraemic symptoms, such as coma and convulsions. At times a nephritis may develop in the course of a blackwater attack and the case subsequently run as one of severe nephritis.
Very striking is the rapidly developing anaemia, some cases showing a loss of two million red cells in twenty-four hours.
The mind is usually clear throughout an attack, the patient showing restlessness and marked anxiety.
In mild cases the fever course and haemoglobinuria is over within twenty-four hours leaving the patient far more prostrated than would a malarial paroxysm. In severe cases, however, the fever runs a remittent course over several days, with more marked haemoglobinuria and jaundice.
There may be cases which only show haemoglobinuria. These apyretic cases have been considered by some as quinine haemoglobinuria.
Symptoms in Detail
Fever Course.—This resembles that of a malarial paroxysm and may be intermittent in character or last several days as a remittent fever. The rigor which accompanies the febrile rise is intense.
The Liver and Spleen.—As a result of the marked blood destruction the liver is unable to dispose of the haemoglobin outpouring and icterus, which usually comes on in a few hours and is intense, is almost constant together with epigastric distress, bilious vomiting and tenderness and slight enlargement of the liver. The spleen is also somewhat enlarged and quite tender.
The Circulatory System.—At first the pulse is rapid with tension but soon it becomes weak, compressible and of low tension. In severe cases it may have a rate of 150 or more or even become thready.
The Genito-urinary System.—The dark colored urine is pathognomonic of the disease and gives it its name. The reddish to almost black color is due to haemoglobin and not to bile. Bile pigments do not appear in the urine. There is but rarely a red cell to be found in the granular débris with occasional haematoidin crystals which forms the urinary sediment, hence it is haemoglobinuria and not haematuria.
The urine resists decomposition for a long time. Albumin is present in large amount and comes on with the onset of haemoglobinuria. Casts are abundant and urobilinuria is marked. As a result of the blocking up of the renal tubules with haemoglobin casts pain over the loins and anuria may occur. There may be vesical tenesmus.
The Blood.—Cases have been reported where as many as 2,000,000 red cells have been destroyed within twenty-four hours, so that rapid and marked anaemia characterizes the disease. The blood is thin and the serum tinged. The degenerative changes of the red cells are not as commonly seen as one would expect but this is probably due to the fact that degenerated cells are first destroyed in the excessive haemolysis. Hb percentage reduction generally parallels the reduction in red cells. Melaniferous leucocytes may be found and during the leucopenia, which follows the paroxysm, the large mononuclears and transitionals may be increased to 20%. There is a reduction in the alkalinity and coagulability of the blood.
Diagnosis
Clinical Diagnosis.—An unusually asthenic prostrating paroxysm, similar to that of a malarial chill, but with more intense rigor, during which haemoglobinuria, early jaundice and marked bilious vomiting are features, makes for a diagnosis of blackwater fever.
The two diseases which are most likely to be confused with blackwater fever are yellow fever and bilious remittent malarial fever.
In infectious jaundice the jaundice does not appear for 48 to 72 hours, the pulse is slow, there is no haemoglobinuria, although there may be a haematuria, and we have a polynuclear leucocytosis.
A case of paroxysmal haemoglobinuria occurring in a blackwater district would[62] be impossible to differentiate from a very mild case of blackwater fever. Chlorate of potash or carbolic-acid poisoning, or snake bite, or severe burns, may produce haemoglobinuria.
| Blackwater fever | Yellow fever | Bilious remittent | |
| Onset | Sudden but asthenic with marked rigor. | Sudden but asthenic for two or three days. | Comes on more slowly. |
| Urine | Haemoglobinuria. Pink foam to urine. Albuminuria from first day. | No blood in urine before 3d or 4th day and then haematuria. Albumin from 2d day. | Bile in urine. Yellow froth on shaking urine. Albuminuria slight and not common. |
| Icterus | Early and intense. Comes on in a few hours. | Does not appear before 3d day and gradually intensifies. | Jaundice develops slowly about 2d day. |
| Spleen | Somewhat enlarged and tender. | No enlargement of spleen. | Splenic enlargement is marked; may have ague cake. |
| Pulse | Rapid from start and becoming more so as disease progresses. | Stationary pulse with rising temperature or falling pulse with stationary temperature. (Faget’s law.) | Pulse not so rapid as in blackwater. |
| Vomit | Early marked bilious vomiting. | Mucus-like followed by black vomit about 4th day. | Bilious vomiting and gastric distress less than in blackwater. |
| Evidences of malaria | Usually present as parasites or melaniferous leucocytes or increased large mononuclear percentage. | Negative unless yellow fever occurs in a malarial case. | Some evidence at some time almost always obtainable. |
Laboratory Diagnosis.—Other than the noting of evidences of malarial infection, rapid reduction in red-cell count and haemoglobin percentage there is little information to be derived from the blood which is thin and shows delayed coagulation time. It is difficult to make good blood smears. In the urine we note the granular sediment of débris[63] of red-cell destruction with at times haematoidin crystals. Spectroscopically we get absorption bands of methaemoglobin and more rarely oxyhaemoglobin.

Albumin is present in quantity and urobilin is usually present in large amount.
One can examine the urine for blood by the haemin-crystals, guaiac or benzidin tests.
Burkitt has noted that his cases of blackwater have shown a very acid urine with large amounts of acetone bodies.
The serum shows haemoglobinaemia and may show reduced alkalinity.
Prognosis
So far as statistics go the mortality rate would appear to be influenced by the delicateness of the tests used for determining the presence of haemoglobinuria. When a diagnosis is only made with the presence of marked haemoglobinuria, showing porter-colored urine, the mortality rate is, of course, higher than when slight haemoglobinuria is taken into consideration.
In cases treated with quinine, Deaderick, in statistics of various authorities, gives a death rate of 25.9%; in cases not so treated, of 11.1%.
Marked and persistent vomiting and hiccough are very unfavorable signs. In particular, however, it is anuria that gives us our greatest concern in the care of a case. A severe attack is followed by a marked anaemia and convalescence is usually protracted.
Prophylaxis and Treatment
Prophylaxis.—The view now generally entertained is that where malarial prophylaxis is properly carried out there will not be any blackwater fever. In persons who have had a previous attack of blackwater fever quinine prophylaxis should be with quinine tannate or quinine base, avoiding the acid salts of quinine.
In particular any exposure to chilling influences or conditions which lower resistance should be avoided. As blackwater fever is more prevalent among those who have been for 2 or 3 years in highly malarious, tropical regions than among recent arrivals, the former should exercise the greater care as to errors in diet, alcoholic excesses, exposure to wet and irregularity in quinine prophylaxis.
Treatment.—There is less unanimity of opinion as to the advisability of giving quinine during an attack of blackwater fever than exists as to any other therapeutic measure.
Of course if it be true that quinine base is devoid of haemolytic influence the fear of increasing haemolysis by giving quinine would not have to be considered. At any rate any red cells containing parasites will surely be destroyed in the general haemolysis and with them their contained parasites, so that it does not seem reasonable to give quinine during the first day or two of the attack. Quinine, if given, should not be by mouth for fear of increasing the nausea and vomiting. The majority of authorities hold that if parasites persist after two or three days from the onset quinine is indicated. Some give quinine during the first day if parasites are present but otherwise they withhold quinine.
Absolute rest in bed, avoidance of chilling and good nursing are the prime considerations in treatment.
The patients should be given alkaline waters freely, as Vichy or water containing 30 grains of bicarbonate of soda to the pint. Cracked ice often tends to lessen the nausea and vomiting. Albumin water or barley water may be retained better than milk or broths. As the condition is so asthenic one cannot disregard the nourishment of the patient during the first two or three days as is true of the sthenic first stage of yellow fever. Hot fomentations to the loins are indicated for relief of pain and the effect on the renal congestion.
Saline enemata are of particular value and may suffice in mild cases. In severe cases subcutaneous or intravenous saline injections are necessary. Sorel recommends the intravenous injection of lactose or glucose solutions in quantities of about 300 cc. (Crystallized glucose 47 grams, water 1000 cc. or C. P. lactose 92.5 grams, water 1000 cc.) He also uses these sugar solutions as enemata. Dry cupping or hot fomentations over the loins are the usual remedies in threatened suppression of the urine. If blackwater fever should be shown to be accompanied by diminished alkalinity of the serum then the intravenous injection of a 1 or 2% solution of bicarbonate of soda would be indicated. Some have recommended calcium lactate in doses of 20 grains every four hours. There is little evidence however to indicate that it is of value. Transfusion of blood has been practised but reports of such treatment indicate that while temporary improvement occurs yet this is followed by a return of haemoglobinuria. From Dudgeon’s work it would seem that the existing haemolysins would destroy the foreign red cells.
Burkitt claims excellent results by intravenous injections of alkaline solutions, similar to those recommended under “cholera.” He also finds neosalvarsan of the greatest value in treatment, as cases so treated convalesce most rapidly.
Hearsey advocates a mixture in which there is contained 10 grains of bicarbonate of soda and 1/30 grain of bichloride of mercury in each dose, to be given every two hours.
Cholesterin has been given in 15-grain doses in suspension in thick milk every four hours with the idea that it is anti-haemolytic. The dose is repeated 2 or 3 times.
Calomel in large doses has been recommended by some tropical practitioners but it would seem advisable only to use calomel to keep the bowels open and then in small divided doses.
Antipyretics should not be used from their depressing action on the heart.
For the urinary suppression, Wallace recommends salines as hot as can be borne, administered high in the colon by a double-flow tube. Since he found this treatment effective after intravenous and rectal injections had failed, it is to be inferred that the results obtained were due not to the further administration of fluid but to the action of heat applied directly to the splanchnic area.
CHAPTER III
THE TRYPANOSOMIASES
Definition and Synonyms
Definition.—African trypanosomiasis is an important protozoal disease of Central and West Africa, due to a flagellate, Trypanosoma gambiense, and transmitted by a tsetse fly, Glossina palpalis. The trypanosome undergoes a developmental cycle in the fly which does not become infective until after about twenty days. The period of incubation is about two or three weeks, after which an irregular fever with approximately normal morning temperature and high evening rise appears, attended with a rapid pulse rate at all times. This is called the stage of trypanosome fever and may show trypanosomes in the peripheral blood. Later on the glands enlarge and gland juice shows trypanosomes. With the appearance of a fine tremor of the tongue, a state of apathy or lethargy, known as sleeping sickness, sets in, attended with trypanosomes in the cerebro-spinal fluid. Gradually increasing mental deterioration marks the almost invariable course to death. A more virulent type of trypanosomiasis is found in Rhodesia.
In Brazil there is a disease caused by a flagellate, Schizotrypanum cruzi, which resembles a trypanosome and is transmitted by a bug, Lamus megistus. The disease runs an acute course with a high fever and great mortality in infants showing chiefly manifestations of involvement of brain or thyroid gland. In adults it runs a chronic course showing neurological manifestations or signs of myxoedema or even of Addison’s disease.
Synonyms.—Sleeping sickness; Negro lethargy. French: Maladie du sommeil. German: Schlafkrankheit. For the Brazilian trypanosomiasis, Schizotrypanosomiasis; Chagas’ disease.
History and Geographical Distribution
History.—In describing sleeping sickness, in 1803, Winterbottom brought out the importance of enlargements of the posterior cervical glands (Winterbottom’s sign).
In 1880 Evans had found a trypanosome in the blood of horses affected with surra and several years afterward Bruce discovered that nagana, a fatal disease of cattle, was due to a trypanosome, T. brucei. In 1890 Nepveu found a trypanosome in the blood of a man in Algeria but owing to vagueness of description the discovery did not attract attention.

In 1901, Forde found a parasite in the blood of a patient in the River Gambia Colony who had a fever and in 1902 Dutton recognized the parasite as a trypanosome and gave it the name T. gambiense. In 1902, Castellani, finding a trypanosome in the cerebro-spinal fluid of a patient with sleeping sickness, brought about the establishment of the connection between the trypanosome in the blood (trypanosome fever) and the trypanosome in the cerebro-spinal fluid (sleeping sickness). In 1903, Bruce and Nabarro reported that this disease was spread by a tsetse fly, Glossina palpalis.
In 1910 Stephens and Fantham brought forward the existence of a more virulent trypanosome, T. rhodesiense.
Geographical Distribution.—The disease exists on the West Coast of Africa, from Senegal to Mossamedes. It is also present in the Congo basin and particularly in Uganda. The more virulent form is found in Rhodesia.
Etiology and Epidemiology
Etiology.—The African trypanosomiases follow infection with two species of trypanosomes; the more virulent type of the disease, occurring in South Central Africa, being due to Trypanosoma rhodesiense, transmitted by Glossina morsitans and that of less severe type, but of[68] more general distribution, being due to T. gambiense and transmitted by Glossina palpalis. The very important Trypanosoma brucei, which is the devastating agent in the African horse, dog and cattle disease, nagana, is also transmitted by Glossina morsitans and there exists the opinion that this trypanosome is identical with T. rhodesiense.
Macfie has reported a new trypanosome, T. nigeriense, from young persons in Nigeria. It is said to be less virulent than T. gambiense, and to be transmitted by Glossina tachinoides.

Bruce considers T. nigeriense as being T. gambiense. Macfie noted many short stumpy forms in animals inoculated with T. nigeriense.
These trypanosomes are blood flagellates and are typical of the Binucleata in possessing two chromatin-staining areas, the larger and more centrally situated mass being the tropho or macronucleus and the smaller, but more deeply staining one, the kineto or micronucleus (Blepharoplast). Trypanosomes have a fusiform or fish-shaped body which stains blue. Near the less pointed, nonflagellated end, usually called the posterior end, is the deeply stained blepharoplast. Adjoining this is a vacuole and, taking origin from this part of the trypanosome, is the flagellum. This borders an undulating membrane attached to the body and then, carried along to the other extremity, projects free as a long, whip-like flagellum.
In fresh preparations the body of the trypanosome progresses in the direction of its flagellated end, although occasionally it will be observed to move in the opposite direction.
Some trypanosomes show granules at certain stages and it has been observed that the extrusion of these granules precedes disintegration of the trypanosome. It has been suggested that such granules might be infective, explaining the infectivity of blood from which trypanosomes[69] were absent. In the separation of trypanosomes into groups and species Bruce relies upon morphology, action on animals, and manner of development in the tsetse fly. He does not consider serum diagnosis and cross inoculation methods as reliable for differentiation. The human trypanosomes are polymorphic.
T. gambiense varies much in length and breadth. The normal type, as found in the blood, varies from 14 to 20 microns, while longer forms, 20 to 24 microns, are growth ones and, in the longest ones (23 to 33 microns), we have those preparing to divide longitudinally. The normal short forms are the ones from which the development takes place in the tsetse fly. In width these flagellates are from 1.5 to 2 microns. The blepharoplast is oval and the nucleus situated about the center.

With T. rhodesiense the nucleus is typically located almost adjacent to the blepharoplast. As a matter of fact it may require the passage of this trypanosome through rats to bring out these “posterior nuclear forms,” the nuclear location being at times almost entirely that of T. gambiense. In addition to the characteristic of nucleus being near the blepharoplast, this trypanosome is more virulent for laboratory animals than T. gambiense, agreeing in this respect with the more severe clinical course in man.
When the tsetse fly, Glossina palpalis, feeds on a man in whose peripheral circulation there are normal type trypanosomes we have an accumulation of such forms in the middle and posterior portions of the gut. From the eighth to the eighteenth day long, slender forms develop and pass forward into the proventriculus. None of the intestinal forms can cause infection when injected into animals. These proventricular[70] types work their way into the salivary ducts and thence into the salivary glands, where further development takes place. Here we have shorter forms developing, which are similar in morphology to the normal blood type. It is at this stage that the fly becomes infective by the passing of these trypanosomes down the salivary ducts and through the channel in the hypopharynx to the subcutaneous tissues of the person bitten. High temperatures, 75 to 85°F., are favorable to development, while low temperatures, 60 to 70°F., are inimical to development, but do not kill the ingested trypanosomes. This explains the long period which at times elapses before a fly becomes infective. Under favorable conditions a fly becomes infective in twenty to thirty-four days and remains infective the rest of its life, up to 185 days. The infection is not transmitted to the pupa. This is an inoculative, cyclical or indirect type of infection. It is usually considered that a tsetse fly whose proboscis has just been contaminated with trypanosome blood is capable of transferring the infection for a few hours. This would be a mechanical or direct method of infection and such power for infection only lasts for a few hours.
There are other groups of trypanosomes, not important for man, in which the cyclical development does not include the salivary glands. In the T. pecorum group of small monomorphic trypanosomes development takes place only in intestines and proboscis, while in the T. vivax group this occurs in the proboscis alone.

When tsetse flies feed on animals infected with trypanosomes only from 2 to 6% become infective. Again, it has been shown that where the wild animals on which tsetse flies feed may show an infection of from 16 to 50% yet not more than 2 out of every 1000 tsetse flies, caught and tried out on susceptible animals, show themselves infective.
Both of the human trypanosomes of Africa have been cultured by using the N.N.N. medium in which rat’s blood was substituted for that of the rabbit. Human blood will also serve as a substitute. Growth however is not constant.
Epidemiology.—Practically the only method of transmission of the disease is by the bite of infected tsetse flies. The female gives birth to a single, yellowish brown, motile larva, which is almost as large as the mother and which, upon reaching the ground, bores its way into a coarse, sandy soil for a depth of about two inches and then becomes a pupa. The larval stage in the mother lasts about two weeks and the pupal stage about a month.
The tsetse fly is much like Stomoxys, but has a branching of the feathering of the arista, long palps, a bulb to the proboscis and a characteristic upbending of the fourth longitudinal vein to meet the mid-cross vein. The female deposits her larva near a shady place upon loose, dry, sandy soil. Moisture and sunlight are not favorable for pupal development, the sun being particularly injurious, so that pupae, buried only an inch deep and away from shade, are killed. This fact has been utilized in prophylaxis by cutting down the trees. The trouble is that the bush growth which soon follows is favorable as providing shade for the pupae.
Male and female flies bite and transmit the disease. They bite in the daytime, usually from 9 A.M., to 4 P.M., and will bite in the sunlight.
It has been stated that tsetse flies are attracted by persons wearing khaki clothing.
With a view to eradication of the disease certain areas have been depopulated, but upon examining the flies caught in the district a year or more later, infected flies have been obtained. This would indicate some other reservoir than man. It is now generally conceded that the trypanosome strain in the antelope is the same as T. rhodesiense, both being transmitted by G. morsitans.
Taute, however, believes them different as he not only injected blood containing such trypanosomes into himself, with negative result, but also allowed flies which had fed on antelopes, which were infective for laboratory animals, to feed on himself, likewise with negative result. It is a well-known fact that men in good condition are refractory to trypanosome infection so that this courageous experiment does not prove the antelope strain to be different from the human one.
One measure that has been proposed is to kill off the big game from a certain area with a view to depriving the flies of their main source of infection.
The probabilities of an animal reservoir for T. gambiense however is not so well settled. Many think that we may have trypanosome carriers and that such persons in the enjoyment of health may act as reservoirs of the virus. Koch suggested that crocodiles were important factors in the life of the tsetse flies and recommended the destruction of the crocodile eggs.
Koch noted the infection of 15 women in a fly-free district and considered their infection as coming from sexual intercourse with their husbands, who had returned home from fly districts where they had contracted trypanosomiasis.
This same method of infection of prostitutes has quite recently been brought to notice by Bernard.
It will be remembered that dourine, a trypanosome disease of horses, caused by T. equiperdum, is transmitted by the sexual act.
All observations however indicate that the spread of the disease is almost exclusively through the medium of the tsetse fly. Professor Lanfranchini was infected in his laboratory by a strain which was supposed to be Trypanosoma brucei.
Pathology
The chief pathological findings are the enlargements of the lymphatic glands. The dura mater may be adherent in places and the pia mater may show areas of thickening. The cerebro-spinal fluid is increased in amount. The pathological process is a chronic polyadenitis which is followed by a chronic inflammation of lymphatics of brain and spinal cord.
We have a meningo-encephalitis in which the most characteristic feature microscopically is a widespread perivascular infiltration of small round cells surrounding the vessels of the pia-arachnoid of both brain and cord. The process is most marked about vessels of pons and medulla. The nerve cells are but little affected other than those of the bulbar nuclei.

Symptomatology
The Period of Invasion.—After an incubation period which may be as short as ten or twelve days, following the bite of an infective tsetse fly, the trypanosomes may be found in the blood or in gland juice. One case has been reported where an official of the Belgian Congo showed trypanosomes less than four weeks after his arrival in the colony. His first symptoms were noted about ten days after his arrival.
In natives, trypanosomes may be present in the blood for long periods of time during which they may do heavy work; thus 7 of Koch’s 52 native porters showed trypanosomes. In Europeans however the course of the disease is rarely so insidious but rapidly enters upon the stage of trypanosome fever.
The Stage of Trypanosome Fever.—Although fever may be absent in natives until the onset of the period of sleeping sickness, yet in Europeans[73] there are usually noted febrile paroxysms, lasting for a few days, and followed, by afebrile periods varying from a few days to two or three weeks.
The temperature curve is of a markedly remittent type, approaching normal in the morning and going up to 103°F. or higher in the evening—a wide daily range. Very characteristic is a low-tension rapid pulse which often is as rapid when the temperature approximates the normal as when it is higher. Early in the disease there are evidences of involvement of the nervous system, as shown by headache insomnia, difficulty of concentration for mental work and cardiac instability.

Winterbottom Sign.—Very important are the glandular enlargements, particularly of the glands of the posterior cervical triangle (Winterbottom’s sign), which upon puncture may show trypanosomes when the blood examination fails to reveal them. The glands are discrete, soft, usually painless and may show but very slight enlargement. Oedematous swellings, especially about the eyes or joints or in localized areas upon the trunk, may be rather prominent in some cases.[74] In Europeans pinkish erythematous rings appearing early in the infection may make one think of syphilis. These erythematous patches are not visible on the skin of natives. A dryness of the skin is rather constant and, especially in natives, papules which itch greatly may be present. Rarely such manifestations as orchitis or choroiditis may be observed.

Kérandel Sign.—Recently great prominence has been given to a deep hyperaesthesia, which shows itself as a lively pain, often retarded, after some slight blow upon a bony projection of the body. Kérandel, who suffered from trypanosomiasis, noted that the fear of striking against objects became with him an absolute obsession. It is called the Kérandel sign. It is during this first stage, when the trypanosomes are to be found only in the blood or gland juice that the disease would appear to be[75] curable. Upon the appearance of the trypanosomes in the cerebro-spinal fluid (second stage) we have practically a hopeless prognosis.
There may be a latent period of several months in which health seems normal, to be followed by the sleeping-sickness stage. It has also been noted that untreated cases, as well as those receiving more or less treatment, may remain in good health for periods up to several years. There is therefore reason to believe that certain cases may not enter upon the sleeping sickness stage.

The Stage of Sleeping Sickness.—In this stage the mentality becomes more weakened. The native from being happy and willing to work becomes morose and apathetic. This change of disposition is frequently the first thing to be noted in a patient by his family. There is a tendency to gaze into the distance. The speech is rather low and[76] tremulous like that of a tired, sleepy child. The tongue especially shows a decided tremor which may also be present in the lips and hands.
The gait is one of weakness and apathy—a shuffling gait. The reflexes may be exaggerated. Romberg’s sign may be present but the Argyll-Robertson pupil has not been noted. There may be an alternation of periods of crying and laughing which with the occasional exhibition of intention tremor and rarely nystagmus may make one think of multiple sclerosis. The patient tends to sleep even when lying in a bright sunlight. Again he may go to sleep with a morsel of food in his mouth. Notwithstanding the apparent stupid state of the patient, he will, when aroused, answer fairly intelligently but with apathy and retardation. The hebephrenic and catatonic manifestations of dementia praecox may be exhibited in some cases.
Finally the patient becomes weaker and more emaciated. The pulse becomes rapid and feeble, the blood pressure being extremely low. The mouth becomes dry, the teeth covered with sordes and bed sores develop. There may be convulsions. The coma and general weakness become more marked and the patient dies. Frequently terminal pneumonias or dysenteries bring about the end.
The sleeping sickness stage rarely lasts longer than a year and even with treatment not more than two years.
The Symptoms in Detail
The Nervous System.—Headache and lack of mental concentration may be early features of the disease. Deep hyperaesthesia, or Kérandel’s sign, often present. Patients tend to be morose and apathetic. Tremor of tongue and lips are rather constant signs about the commencement of the stage of sleeping sickness. Early insomnia gives way to the drowsiness that characterizes the second stage. There is very little disturbance of sensory or motor functions until near the end. Epileptiform convulsions may be late manifestations. Coma deepens as the end approaches.
The Temperature Curve.—The febrile paroxysms, which may not be present in natives until the sleeping-sickness stage, show great irregularity of course and a marked remission in the morning. The fever may be absent for several weeks to return later. Trypanosomes are more apt to be present in the peripheral circulation during the fever than when the temperature is normal.
The Circulatory System.—The pulse tends to run from 90 to 120 beats per minute and is fast even without fever. The tension is low and the systolic pressure tends to be extremely low during the later stages of the disease.
The Lymphatic System.—Most important in diagnosis is the enlargement of the lymphatic glands, especially those of the posterior cervical triangle (Winterbottom’s sign). Other enlarged glands may be the supraclavicular, epitrochlear and axillary glands. The inguinal glands suffer enlargements so frequently as the results of wounds and infections of the foot that their enlargement is of less diagnostic value. The natives of certain parts of Africa not only attach great diagnostic importance to gland enlargement but they imagine they cure the disease by removing the glands with various primitive cutting tools. The glands are not painful, do not become matted together and rarely suppurate. Our best means of diagnosing[77] trypanosomiasis is by withdrawing gland juice with a syringe and examining the smears.
The Skin.—Erythematous areas may be present in Europeans. Localized oedemas are rather marked features. The skin may be very dry and itch markedly.
Other Manifestations.—The spleen may be enlarged, the respirations may be more rapid than normal and the blood show a secondary anaemia. In a blood examination the large mononuclears show an increase with a normal white count.
The eye may show keratitis or irido-cyclitis in trypanosomiasis.
Trypanosomiasis seems to favor abortion and still-births, in this respect resembling syphilis.
Diagnosis
In making a survey of a native population Schwetz considers gland palpation as almost as reliable as gland puncture and of course more expeditious. The typical gland should be large and soft or elastic although he admits trypanosomes may be found in small hard glands.
When the glandular enlargement is distinct, with the erythema and headache, there is much that suggests syphilis. Another point of confusion is that positive Wassermann tests are often obtained in sleeping sickness.
The increase in large mononuclears goes with malaria, kala-azar and syphilis as well as with trypanosomiasis so that such findings are of little assistance in differential diagnosis.
An early history of attacks of fever, with marked fluctuation of temperature, associated with rapid pulse, even with the apyrexial morning fall, is suggestive. Then with the glandular enlargements we think immediately of laboratory examinations. As with pellagra the history is very important in the diagnosis of trypanosomiasis.
For the laboratory diagnosis we may use peripheral blood with some thick film method. The examination of preparations from the peripheral blood is usually very discouraging. Very much better results (in fact some prefer this method to any other) can be obtained by taking 10 to 20 cc. of blood in about 25 cc. of citrated salt solution, centrifuging 2 or 3 times and examining the sediment of the third centrifugalization. Dutton and Todd prefer to centrifuge citrated blood and to collect the leucocyte layer for examination as is done in opsonic work.
Gland Puncture.—The English workers usually prefer the gland puncture method, using a sterile but dry hypodermic needle. Water in the needle distorts both leishman bodies and trypanosomes.
In the sleeping-sickness stage trypanosomes can almost constantly be found in the cerebro-spinal fluid.
In a diagnostic study of 336 cases Broden obtained 87% of positives from gland puncture, 80% from centrifugalizing the supernatant fluid left from the second centrifugalization of the blood and 4.5% from spinal fluid examinations.
Some prefer to inoculate susceptible animals, particularly the guinea pig or monkey, with blood or gland juice from the suspected case. A very satisfactory material is an emulsion from an excised gland which may be inoculated intraperitoneally into white rats. The further course, after animal inoculation, is the examination of the blood of these animals for trypanosomes. Usually at the time the guinea pigs die we find numerous trypanosomes.
Other tests are: (1) Trypanolysis, when unheated suspected serum and trypanosomes are incubated together for one hour. Normal serum may occasionally cause disintegration and treated cases give it in only about 45% of cases. Unfavorable untreated cases give it in about 80% of cases.
(2) The so-called auto-agglutination test is not of much value. In this the red cells of the blood of a trypanosomiasis case come together in clumps when one makes a wet preparation. It is not a rouleaux formation. (3) The attachment test is made by making a mixture of inactivated serum, leucocytes and trypanosomes and allowing them to be in contact for 20 minutes. A positive test shows attachment of the trypanosomes to the leucocytes.
Prognosis
If the patient cannot be removed from the infected district or cannot receive the atoxyl or atoxyl-tartar-emetic treatment the prognosis is almost surely that of a prolonged but fatal end.
There is very little hope of cure if the disease has gone on to the sleeping-sickness stage.
Prophylaxis and Treatment
Prophylaxis.—The question of depopulation of districts and destruction of the big game therein, when the area is infected with Glossina palpalis, has been fully considered under epidemiology.
Isolation, in the fly-free districts, of infected natives has not proven a very practical measure but that of rendering their peripheral blood free of trypanosomes by atoxyl injections would seem more desirable. In this we aim to cure the patient as well as render him safe to others.
The most practical measure is that employed in Uganda of clearing the plant and tree growth for at least fifteen feet from the streams of water, it having been noted that the tsetse flies confine themselves to a narrow strip not more than fifteen feet from the water’s edge. The tsetse fly requires considerable moisture for its existence.
The catching of flies in traps or with a sticky lime does not offer much encouragement.
As regards personal prophylaxis, white clothes are to be worn as the tsetse fly, along with mosquitoes, prefers dark-colored garments. The[79] legs should be protected by leggings and possibly one could consider the wearing of gloves or veils. As a matter of fact, however, the heat of the tropics precludes these latter measures. As the fly only bites in the daytime one should choose the night for going about, if practicable.
Treatment.—The general opinion is that trypanosomiasis is only curable at a time prior to the appearance of trypanosomes in the cerebro-spinal fluid. Consequently, the stage of sleeping sickness offers little chance of cure by treatment.
Such cases have been treated with injections of 10 cc. of 1 to 1000 solution of neosalvarsan into the spinal canal, after withdrawing about 15 cc. of spinal fluid, but without appreciable curative effect. On the assumption that trypanosomes invading the central nervous system are protected from drug action, Marshall proposed the injection of salvarsanized serum intrathecally. Three hours after the administration of 0.6 gm. of salvarsan enough blood is withdrawn from a vein to give about 20 cc. of serum. Following the withdrawal of a slightly greater amount of cerebro-spinal fluid from 5 to 20 cc. of the serum is injected in its place. Yorke in a critical article on the claims for this treatment is of the opinion that there is no satisfactory evidence that such a method sterilizes the infected cerebro-spinal fluid. He cites cases where the trypanosomes disappeared from the spinal fluid after ordinary treatment and where cases lived for extended periods after trypanosomes were found in their spinal fluid. Corbus and associates have described a new method of obtaining a high medicinal content in the cerebro-spinal fluids. Their work was done with neo-arsphenamine, but there seems to be no reason why other drugs may not be similarly administered.
The basis of the method is the observation that hypertonic salt solution, injected intravenously, will dehydrate the central nervous system, and that restoration of fluid begins at about the sixth hour. If a drug is injected into the circulation just at the time when the restorative formation of spinal fluid is taking place, it appears that a large quantity is carried into the subarachnoid spaces with the fluid, as on a flood tide.
Method:
1. 8 A.M. Patient is put to bed.
2. 10 A.M. Intravenous injection of 100 cc. of 15% saline, warmed and administered slowly by gravity. The symptoms produced by this injection are mild and transitory.
3. No food is permitted at midday.
4. 4 P.M. Neo-arsphenamine is injected with the usual technic.
5. 8 P.M. Light nourishment is allowed. Patient is kept under observation, preferably in bed, for the ensuing thirty-six hours.
Atoxyl.—The first drug to offer hope of cure was sodium arsanilate, atoxyl, which contains about 26% of As. This is best given in doses of about 0.5 gram (7½ gr.) in about 15 cc. of sterile distilled water intramuscularly. Several cases of optic neuritis were reported but the drug is still a standard treatment. We give the atoxyl at intervals of five days, Manson gives 3 grains every third day.
Probably the best treatment is one in which three doses of atoxyl are followed by from 10 to 15 daily or every other day injections of 0.1 gram (1½ gr.) of tartar emetic. The course is repeated after an interval of three weeks. It is advisable to give a hypodermic of caffein a few minutes before the tartar emetic to lessen depression. Kérandel received the atoxyl-tartar-emetic double treatment and ascribed his cure to the tartar emetic. Tartar emetic is also given intravenously, 0.1 gram in 150 cc. water.
Intravenous injection of arsenophenylglycin, in doses of about 1.0 gram. (15 gr.) intravenously has been highly recommended. Recent reports from German East Africa state that of 35 treated with this drug six died of the effects of the drug. Salvarsan and neosalvarsan have been used but apparently without particular success.
A combination of treatments in which salvarsan, sodium salicylate and ethyl-hydrocuprein (a quinine derivative) have been used has been favorably reported by Morganroth where the action of a single drug was of little value.
Very remarkable claims in experimental animals have been made for “trixidin,” a preparation of antimony trioxide which is given intramuscularly. Even inunctions with this preparation have been quite successful in curing infected mice. In larger animals abscess formation is an objection.
Daniels has reported good results from the injection of oxide of antimony. The preparation used is Martindale’s injectio antimonii oxidi given subcutaneously in 30 minim doses (1/20 grain of the oxide). Masters gives this preparation intramuscularly and notes its greater efficiency than any other drug or combination of drugs. He gives 3/100 grain every other day until 40/100 grain has been given. If trypanosomes continue present he gives a .77 gram dose of soamin. Soamin is a drug similar to atoxyl but said to be less toxic.
In the treatment of 18 cases of T. rhodesiense infections Newham notes that tartar emetic alone was as effective as the combined treatment with atoxyl. He gave the tartar emetic injections twice weekly intravenously commencing with 1 grain and going up to 3 grains. An organic antimony preparation, “Stibenyl,” has been recommended. See kala-azar.
Very favorable reports have been made from the use of galyl and ludyl, arsenical compounds.
A drug which is reported to have exceptional trypanocidal effect on animals infected with both human trypanosomes is “Bayer 205.” Dogs infected with the dourine parasite and showing oedema and eye symptoms have been cured by the injection of the drug intravenously. A dose of 0.5 mg. causes disappearance of parasites in mice. It is stated that the drug produces a protection against reinfection which lasts for months.
BRAZILIAN TRYPANOSOMIASIS
General Considerations.—In 1909, Chagas reported the finding of a flagellate in the intestines of Conorhinus megistus or, more properly,[81] Lamus megistus. He was also able to transmit the flagellate to laboratory animals and could culture it on blood agar.

Fig. 33.—Schizotrypanum cruzi in blood of child with acute type of Brazilian trypanosomiasis. (MacNeal from Doflein after Chagas.)
In investigating the matter of the importance of this flagellate, Schizotrypanum cruzi, in Minas Geraes, Brazil, where the above-named bug was present in great numbers in the cracks of the houses of the poor he associated this flagellate infection, which he at first considered trypanosomal, with a disease of the children of that section.
The bug is a vicious feeder and, from its biting chiefly about the face, has been called barbeiro or barber by the natives. Both the male and female of Lamus bite and can transmit the disease and although the parasite is not transmitted hereditarily the nymph is capable of sucking blood and becoming infected.

It requires several months for the insect to go through the egg, larval and pupal stage to maturity. Some consider this bug to belong to the genus Triatoma. The insects may live for more than a year and tend to remain in the same house where they may have become infected but leave such house if it be abandoned by man. Brumpt thinks that the bedbug may also transmit the disease. A large proportion of armadillos in the endemic areas are infected with S. cruzi but do not seem to be affected thereby. It has been suggested that this animal may be a reservoir of virus.

Fig. 35.—Schizotrypanum cruzi developing in the tissues of the guinea pig. 1. Cross-section of a striated muscle fibre containing Schizotrypanum cruzi: Note dividing forms. 2. Section of brain showing a Schizotrypanum cyst within a neuroglia cell, containing chiefly flagellated forms. 3. Section through the supra-renal capsule, fascicular zone. 4. Section of brain showing a neuroglia cell filled with round forms of Schizotrypanum. (From Low, in Sleeping Sickness Bulletin, after Vianna.)
S. cruzi is found in the blood of children during the acute febrile stage but at other times in children, and as a rule in adults, it is rarely present in the peripheral blood. The early blood forms are narrow and very motile. They increase in size and slacken in motility when they become about 20 microns long. S. cruzi is characterized by a very large blepharoplast. Dividing forms are never seen in the blood. The common site of multiplication is in the cells of the voluntary muscles and heart and also in the cells of the central nervous system, adrenals, and bone marrow. In these tissues the flagellate takes on a rounded form and undergoes binary division. Continued division converts the infected cell into a cyst. It is this process going on in various important structures that accounts for the extreme variation in symptomatology and pathology.
Chagas thinks that the gametes for the cycle in Lamus arise from parasites developing in the lungs of the vertebrate host. Flagellated parasites enter the lungs, lose the flagellum and become oval in shape, later on dividing into 8 parts. These assume an elongated form and enter the red cells of the host. Against this is the statement of various observers that the flagellates are only to be found free in the plasma, never within red cells. The forms taken up by Lamus multiply in the intestine and then pass to the salivary glands after about 8 days. The bug is then infectious when it bites. Brumpt notes that infection may occur from inoculation of the faeces passed by the bug, especially through the conjunctiva.
Symptomatology. Acute types.—This form of the disease usually occurs in children under one year of age. The period of incubation is about ten days. It is attended by a high continued fever which may show a slight morning drop. There is marked puffiness of the face and enlargement of the thyroid. The lymphatic glands and spleen are also enlarged. The case may give the picture of a meningitis in which form the disease is exceedingly fatal. During the febrile period parasites are to be found in the blood but in the afebrile intervals which alternate with the febrile ones parasites are not present.
Chronic Types.—The type of the disease as seen in adults is mainly chronic. They often show enlargement of the thyroid and manifestations of myxoedema. The lymphatic glands are enlarged. Where the adrenal is attacked we have the syndrome of Addison’s disease.
In the cardiac types there are present various forms of cardiac irregularities.
In the cerebral types various neurological manifestations may be noted.
An irregular fever may accompany the signs of involvement of the various important organs.
The disease is attended by a marked anaemia.
Diagnosis.—In the laboratory diagnosis of those cases not showing the flagellates in the blood the usual method is to inoculate a guinea pig with the blood and in about two weeks S. cruzi may be found in the blood of the animal. The parasites may not appear, however, in the blood, when one should resort to culturing the guinea pig’s blood or more surely examine sections of muscle of the animal for the forms in the muscle cells undergoing binary division.
Brumpt has recently advocated the xenodiagnostic method. Thus, in a number of guinea pigs infected with S. cruzi, parasites could not be found, but by having third stage larvae of Conorhinus feed on these animals the parasites developed in the bugs. He regards the alimentary tract of these bugs as a most favorable culture medium.
Prophylaxis and Treatment.—Other than destroying the bugs by sulphur fumigation or whitewashing there is little to note. The bugs show a liking for leather articles, as old harness.
The same plan of treatment as for African trypanosomiasis may be tried but such treatment is not effective with infected animals.
In the myxoedema types thyroid extract is indicated.
Note: Escomel has reported the finding of a trypanosome 20 to 40 microns by 3 to 4 microns which had a flagellum as long as the body and with a very small but distinct blepharoplast (unlike S. cruzi) in the blood of a native of Peru. The patient at the time of the blood examination was afebrile and showed a generalized firm oedema. There was noted anaemia, prostration and somnolence. This may be a new species.
TRYPANOSOMIASES OF ANIMALS
Trypanosoma brucei.—This trypanosome causes a surely fatal disease in horses and one from which few cattle recover. It is called “nagana” or the fly disease, from being transmitted by the tsetse fly, Glossina morsitans. All animals except man and possibly the goat seem susceptible. The disease is characterized by fever, oedematous areas about neck, abdomen and extremities, progressive anaemia and emaciation. It is an important disease of domesticated animals of many parts of Africa.
Trypanosoma evansi.—This is the cause of a very fatal disease of horses in India and the Orient and known as “surra.” It also affects camels and even cattle. It is thought to be transmitted by biting flies (Stomoxys). The symptoms are fever, emaciation, oedematous areas and great muscular weakness.
Trypanosoma equinum.—This trypanosome causes a fatal disease in horses in South America. There is paralysis of the hind quarters of the horse which gives the disease the name “mal de caderas.”
Trypanosoma equiperdum.—This trypanosome causes a disease of horses in many parts of the world. It is known as “dourine” and is transmitted by coitus. The genital organs show marked oedema which is followed by anaemia and paralysis.
Trypanosoma dimorphon.—This trypanosome causes a disease of horses in Gambia. It is also found in horses and cattle in other parts of Africa. The parasite shows marked variation in morphology.
Trypanosoma lewisi.—Rats in many parts of the world show this infection which is rarely fatal to them. It is transmitted by the rat flea by a process of regurgitation. It can also be transmitted by the rat louse.
CHAPTER IV
THE TROPICAL RELAPSING FEVERS
Definition and Synonyms
Definition.—There is a group of tropical fevers more or less identical clinically with European relapsing fever and caused by spirochaetes closely allied to Spironema recurrentis (Spirillum obermeieri). It seems probable that the relapsing fevers of East and West Africa are caused by a single species, S. duttoni, which is transmitted by a tick, Ornithodoros moubata, while that of Northern Africa is caused by another species, S. berbera, which is transmitted by lice, either Pediculus vestimenti or Pediculus capitis. Another species of spirochaete, S. carteri, is supposed to cause the relapsing fever of India and it seems probable that its transmission is brought about by infected lice.
Besides the above species of spirochaetes others have been reported, as S. novyi for American and S. persica for Persian relapsing fever. The view taken by Nuttall, that these various names may be of convenience in the study of relapsing fevers but that there is no adequate morphological difference to justify them as species, seems worthy of acceptance. It has been shown that the separation of these spirochaetes on the basis of susceptibility of laboratory animals and cross immunity reactions is untenable. Agglutination of certain strains by their specific sera, however, is a reliable means of separation. As with European relapsing fever, these fevers are characterized by a sudden onset, intense frontal headache, and pain of back and limbs. This fever remains high for three to five days and falls by crisis, to be succeeded by an apyrexial interval of approximately one week. There may be several of these alternating febrile and afebrile periods. The spirochaetes are in the peripheral circulation during the febrile period but not in the afebrile one. The spleen is enlarged and tender. Cases showing jaundice seem more grave.
Synonyms.—Febris recurrens. Tick fever. French: Typhus recurrent. German: Rückfallfieber.
History and Geographical Distribution
History.—Although Hippocrates described the clinical features of relapsing fever quite accurately this knowledge seems to have been lost until about the eighteenth century.
The causative spirochaetes were first seen by Obermeier in the blood of a patient in 1868 but he did not publish his discovery until 1873.
Ross and Milne, in 1904, found that African tick fever was a spirillar fever while Dutton and Todd established the fact of its transmission by ticks.
Geographical Distribution.—Relapsing fever was epidemic in the U. S. in 1869, since which time it has not reappeared. There have been many epidemics in Ireland, Russia, Turkey and other parts of Europe. It was a disease of importance during the Balkan War of 1912-1913. China and India have frequently been visited by epidemics as well as the Philippine Islands and the Dutch East Indies. Uganda, Congo State and German East Africa, as well as Egypt and Algeria, are important centers. There is also a relapsing fever of Colombia and Central America.
Etiology and Epidemiology
Etiology.—Relapsing fevers are caused by organisms generally considered as protozoal in their nature and belonging to the flagellates.

Transmission by the tick.—The generic name Spiroschaudinnia is preferred by some to the more commonly accepted Spirochaeta. Recently, authorities give these organisms the name Spironema. East and West African relapsing fever, or tick fever, is caused by Spironema duttoni and the transmission is through the bite of an argasine tick, Ornithodoros moubata. Not only does the tick itself become infected by the taking in of blood-containing spirochaetes but likewise transmits the infection to its progeny. Leishman considers that when the spirochaetes are taken into the alimentary tract of the tick there is a breaking up of the spirochaetes into small granules which reach the Malpighian tubules. They also invade the ovary and the ova. It was thought that these granules were the infecting agents and that they were excreted in the fluid of the coxal glands or passed out with the faeces. More recently[88] it has been claimed that these granules have no relation to the infection, which is due to spirochaetes as such.
It may be stated that spirochaetes as such may be found in the secretion of the coxal glands as well as in the faeces. This coxal fluid dilutes the thick faeces and makes an emulsion which is smeared out by the body of the tick in the area of the bite puncture.

At any rate this infection of man seems to be the contamination method, the material from faeces and coxal glands being rubbed into the wound made by the tick-bite. The ticks hide in the cracks about the old native huts and bite the sleeping inmates. There may be quite a local reaction at the site of the bite. Spironema duttoni has been cultured by Noguchi, by utilizing his methods for culturing the organism of syphilis. In such cultures he has noted longitudinal division rather than transverse, this fact rather favoring a protozoal as against a bacterial nature. This spirochaete is from 24-30 microns long, about 0.45 micron broad and has a corkscrew motility. It is readily transmissible to a number of laboratory animals, as monkeys, white rats, etc. The spirochaete of Northern African relapsing fever, S. berbera, causes the disease as seen in North Africa and Egypt. It is transmitted by lice, Nicolle and others having shown that the spirochaetes make their way from the alimentary tract to the body cavity of the louse. They have shown that the bite alone of an infected louse is innocuous and also that the faeces are non-infective, when injected into monkeys. Emulsions of infected lice, however, when rubbed into wounds, produce the disease in monkeys.
Transmission by the Louse.—The spirochaetes taken in by a louse disappear in a few hours and the insect remains harmless until about the fifth day, when it becomes infectious, and so remains until the twelfth to fifteenth day. Spirochaetes reappear in the coelomic fluid of the louse about the sixth day and continue present until about the twentieth day.
A striking fact is that infection can be brought about a day before spirochaetes appear and that after a period of a few days these spirochaete-containing lice lose their power to infect. It would seem that the infecting stage was an invisible one. Have we then a symbiosis between a spirochaete and an invisible virus, possibly filterable? Wolbach has shown that certain spirochaetes will pass through a Berkefeld filter as spirochaetes but this would not affect the possibility of the existence of some granule or chlamydozoal stage. It may be that the infecting stage is not an invisible one but a granule one.
Mode of Infection.—It is by crushing the louse, by scratching or otherwise, that the spirochaetes contained in the coelomic fluid reach and penetrate the wound of the bite. This is therefore a contaminative method of infection. Mackie has shown that the Indian relapsing fever, which is caused by S. carteri, is probably transmitted by the louse, and it is probable that the conditions under which the infection takes place are similar to those occurring with S. berbera infections. With the European relapsing fever, bedbugs may possibly act as transmitting agents. The probabilities however are that this infection is transmitted by lice alone.

A relapsing fever of Persia is transmitted by a tick of the genus Ornithodoros, which is also true for the relapsing fever of Panama. There is great variation in the description of the different spirochaetes, and frequently measurements are given for short forms and long forms. They also vary from wave-like lines to corkscrew spirals. Again, different species have different types and different activities of movement. As a rule they are about 20 × 0.4 microns. The spirochaetes of the relapsing fever of Panama varied in length from 4.6µ to 22µ. Of these the most common were those measuring 13µ. Transverse division of the longest forms was seen in dark-field preparations. The monkey is susceptible to all species of relapsing fever spirochaetes. White mice and white rats are readily infected by S. duttoni and the Panama spirochaete but are refractory to S. recurrentis except after passage through monkeys. S. carteri causes only a transient infection in these small rodents.
Epidemiology.—With tick fever the epidemiology rests upon the life history of the tick O. moubata. This tick infests the rest houses along the route of travel, hiding in the crevices of floors and walls during the day and coming out at night to bite the sleeping inmates. The feeding occupies a long time, more than an hour. Both sexes bite man.[90] The female lays about 100 eggs, from which nymphs emerge in about twenty days. The larval stage takes place in the egg. Shortly after emerging the nymphs suck blood. An important fact is that the female transmits the spirochaete to its ova, so that the ticks from such ova may transmit the disease.

Fig. 39.—Siphunculata and Rhynchota. 1. Pediculus capitis. 2. Pediculus vestimenti. 2a. Protruded rostrum of Pediculus. 3. Phthirius pubis. 4. Acanthia lectularia. 5. A. rotundata. 6. Conorhinus megistus.
Natives seem to suffer severely from tick fever in childhood but in adult life possess a sufficient degree of immunity so that the disease shows itself in a very mild form in those harboring spirochaetes.
The immunity conferred by an attack is not lasting and a second infection may occur within a year. Such second attacks, however, do not present the relapses so important in a clinical diagnosis. As a matter of fact there may be no symptoms and such cases with spirochaetes in their blood make ideal carriers for the infection of ticks or lice. Ticks can be infected by these carriers. In some of the rest houses 50% of the ticks may be infected. While the tick does not tend to leave its habitation it may be transported in the bundles of native porters. The transmitting agent of the North African relapsing fever and probably of the Indian type is the louse. The body louse deposits about 75 eggs in the clothes of the host, which hatch out in about four days and become adults in about two weeks. The head louse deposits its eggs or nits on the hair of the host’s head. Hagler has noted that, in Servia,[91] typhus fever disappeared when lice were gotten rid of but relapsing fever continued to prevail until they also exterminated the bedbugs.
The Relapsing Fever of Panama.—Bates, Dunn and St. John have demonstrated that a tick, Ornithodoros talaje, transmits the relapsing fever of Panama. This tick seems to prefer the crevices and open joints of bamboo beds, laying its eggs and moulting in the hiding places. It comes out at night to feed on the occupants of the bed. Two white rats were inoculated with an emulsion made from ticks taken from a suspected bed. Both rats developed a spirochaete infection. A man inoculated with blood of one of these rats developed relapsing fever on the sixth day. A second man was inoculated subcutaneously with an emulsion of ticks collected from a bed and showed spirochaetes in his blood on the eleventh day.
Another man was bitten by ticks from the same source and was instructed not to scratch the bite. The ticks engorged in about 15 minutes, some of them secreting coxal fluid which mixed with blood from the bite made a scab. This man was positive for spirochaetes on the fifteenth day.
Pathology and Morbid Anatomy
The spirochaetes disappear from the peripheral circulation during the apyrexial period, notwithstanding which such spirochaete-free blood, when injected into monkeys, may bring about infection. Either a granule stage or an invisible stage of the parasite may be present. The relapse is probably due to the existence of resistant strains which are not destroyed by the lytic substances, developed during the attack.
Agglutinating and lytic substances show themselves chiefly during the apyretic intervals.
The spleen is enlarged and soft. There are frequent infarctions. The spirochaetes are found phagocytized in the macrophages of the spleen and elsewhere. Parenchymatous degeneration of kidney and heart muscle, and especially of liver, may be noted.
Symptomatology
East and West African Relapsing Fevers.—In African tick fever after a period of incubation of from three to ten days the disease sets in rather suddenly with dizziness, marked headache and general body pains. The temperature quickly rises to 104°-105°F. and remains elevated during this primary febrile period, except for slight morning remissions. Vomiting is quite a feature of this disease and may be bilious in character.
There may be rather marked praecordial oppression and a bronchial catarrh. The pulse in particular and the respiration in less degree are accelerated. Herpes[92] and epistaxis may be noted. The bronchial manifestations seem to occur chiefly in the first febrile accession. The spleen is somewhat enlarged and tender but in many cases this is not noted. Spirochaetes are found in the peripheral circulation during the febrile accessions but not during the apyrexial intervals. There is great variation as to the abundance of spirochaetes. In some cases we may have to search several hundred fields before finding a single spirochaete. Severe cases may show them in abundance. A rather marked leucocytosis may be present in cases showing high fever and bronchitis. After about four days the fever falls by crisis, often below normal, and possibly with great prostration and cardiac weakness.
A critical sweat is a feature of this rapid fall of temperature. During the afebrile period, which lasts from three or four days to eight to ten days, the patient feels much better and his appetite and strength return. With the onset of the second pyrexial wave the severe symptoms of the first days are repeated, as with the first febrile period. This second one terminates by crisis. Iritis is not uncommon. Manson and Thornton have reported transient cranial nerve involvements coming on late in the course of the disease.
In European relapsing fever the second febrile accession is usually shorter and of less severity than the first. Furthermore there are rarely more than 2 or 3 relapses. In tick fever, however, there may be as many as 10 of these febrile recurrences, although there are usually only 4 or 5. In natives there is usually only one febrile period, this probably being due to an immunity resulting from previous infections.
North African Type.—In the relapsing fever of North Africa the attacks are less severe and the number of relapses rarely exceeds three. A fever of Egypt, generally known as the bilious typhoid of Griesinger, is believed to have been a form of relapsing fever. In this there was marked bilious vomiting with great tenderness of the liver, late jaundice, albuminuria, bone pains, especially about the knees, and a high death rate. The symptoms rather suggest yellow fever but this disease has never been reported from Egypt.
Indian Type.—In the relapsing fever of Asia there is a marked tendency for the patient to collapse at the time of the crisis. There are rarely more than two relapses and in probably 25% of cases there is no relapse. There seems to be a greater tendency to liver complications in the Asian types than elsewhere and such cases form a large part of the death rate from this disease. Bilious vomiting and jaundice, with a typhoid-like state and the occurrence of various inflammatory complications, especially parotiditis, are noted. The mind is usually clear, but delirium may be present in severe cases.
Relapsing Fever of Panama.—In three experimental cases the temperature of the first accession varied from 102°F. to 104.5°F. Frontal headache and general body aches were the chief symptoms. Vomiting was noted in one case. The spleen was not enlarged. The first relapse was cut short in each case by arsphenamine.
The Symptoms in Detail
The Temperature Curve.—This is the chief point in the clinical diagnosis of relapsing fever. The onset of the first febrile accession is abrupt and the temperature[93] rapidly rises to 104°F. or higher. After a continued high temperature for three or four days the fever drops by crisis, which is at times productive of collapse. Following an apyrexial period of four to eight days we have a second febrile accession, and there may be several of these wave-like alternations of fever and apyrexia.
The Nervous System.—Very marked frontal headache is a striking feature and the pains in back and limbs may be of great severity. Cranial nerve involvement has been noted. There may be apathy, but on the whole the mind is clear.
The Digestive System.—Anorexia and vomiting are features of the febrile periods to cease in the fever-free periods. In some types bilious vomiting may be marked.
The Circulatory and the Respiratory System.—The pulse rate is much accelerated, and there may be some praecordial distress. A bronchial catarrh is frequently present in the first febrile paroxysm.
The Liver and Spleen.—Splenic tenderness and moderate enlargement are fairly constant features. The liver may suffer severely in the so-called bilious typhoid and marked jaundice may ensue with a typhoid state.
The Blood Examination.—This is the most important point in diagnosis. The spirochaetes, which are only found in the peripheral circulation during fever periods, are not so numerous in tropical relapsing fevers as in the European forms. When spirochaetes are scarce it is more satisfactory to examine Romanowsky-stained specimens, especially with the Giemsa staining. The spirochaetes show a varying number of undulations. There is no chromatin staining in the line of the spirochaetes. The disease when severe shows a well-marked polymorphonuclear leucocytosis, with at times an increase of large mononuclears. This latter, however, may be connected with malaria or amoebiasis.
Diagnosis
The disease most likely to be confused with relapsing fever is malaria and for this differentiation the finding of the parasites of either disease is of first importance.
The blood of a suspected case even during the apyrexial period should be injected into a mouse or white rat (guinea pigs are refractory to infection). Spirochaetes should appear in the blood of the mouse in about twenty-two hours and persist for about two days. Relapses occur but recovery is the rule.
Dengue may be suspected, but the leucopenia, lack of splenic tenderness, lack of tendency to vomiting and presence of post-orbital pains should differentiate. As there is a leucocytosis in both relapsing fevers and smallpox, and similar headache and backache, confusion might exist were the parasites not found.
Yellow fever has many features in common with the bilious type of relapsing fever, but there is no leucocytosis in yellow fever, and there is no characteristic albuminuria and slow pulse in relapsing fever. Influenza has many points in common with relapsing fever.
In a case of relapsing fever with jaundice confusion might arise with Weil’s disease inasmuch as a blood smear might show spirochaete-like organisms.
Typhus fever shows a less abrupt onset and the marked mental symptoms (stupor) and dark macular eruptions about the trunk, on the 4th to 6th day, should differentiate. If the case is first seen in the apyrexial period one may take a drop of blood from a case showing spirochaetes and one from the suspected patient. After incubation for thirty minutes the spirochaetes should lose motility and agglutinate if the case be one of relapsing fever (Lowenthal’s Reaction).
In blood examinations we may use the dark-field illumination, although the spirochaetes stain readily with Wright’s stain. The India ink method is a good one. Hagler recommends smearing out a mixture of one loopful of blood and a collargol preparation made by diluting one part collargol with two parts water. The diluted collargol should stand 24 hours and be filtered before use.
Prognosis
The mortality is usually given as about 2 to 5% with the exception of the very serious form in which jaundice is present when the death rate may exceed 50%.
A serious feature of the disease is the length of its course, this often extending from six weeks to two months.
Since salvarsan and neosalvarsan have been found to be practically specifics in the treatment of the disease the mortality has been reduced to exceedingly low figures.
Prophylaxis and Treatment
Prophylaxis.—The sole question is the avoidance of places infested with ticks, bedbugs and lice. In Africa, the habitations of the natives, where infected ticks may hide themselves in cracks in floors and walls, are to be especially avoided. As the tick feeds at night a night light is of value.
Destruction of the spirochaetes by salvarsan injection is important prophylactically as well as therapeutically—the reservoir of infection for lice or ticks being gotten rid of.
Treatment.—We have in salvarsan, or neosalvarsan, a specific. The drug should be given so soon as the spirochaetes are found—in the period of onset of the fever. If given at the end of the fever it may intensify the critical manifestations, especially collapse. Unless given early it does not abort the relapse. Neosalvarsan, being less[95] toxic, is better adapted to the treatment of the icteric type of the disease. Atoxyl has practically no value in treatment and the same is true of antimony.
Conseil has treated cases with galyl and ludyl, in doses of 4 to 7 grains, with results as good or better than with salvarsan. The pains in the head and back are relieved by aspirin, although a hypodermic of morphine may be necessitated. Cool sponging and fresh-air treatment are desirable. On the whole, treatment, other than the specific one, is symptomatic.
Administration of the Arsphenamines.—Although arsphenamine (salvarsan) is probably the drug of choice when immediate therapeutic effect is desired, neo-arsphenamine is more popular because it is more simply prepared and administered, is tolerated better by the patient and has a slightly higher therapeutic index. It is, however, less stable, and both the powder and its solutions should be inspected carefully for signs of decomposition, namely, a darkening in color, a strong odor, and insolubility. Ampules containing either drug should be immersed in 95% alcohol for 15 minutes in order to detect any crack. Should a breach be found, or suspected, the ampule should be rejected.
Myocarditis, advanced non-syphilitic renal or hepatic disease, advanced arteriosclerosis and Addison’s Disease are regarded as generally contra-indicating the employment of these drugs. Cases in which the syphilis is of long standing should receive mercurials for at least a week prior to the first injection of arsenic, in order to avoid the possibility of activating lesions in vital organs (Herxheimer), and should be closely questioned regarding the occurrence of symptoms following previous injections (idiosyncrasy).
Prior to each injection, a patient should have a complete uranalysis, receive a cathartic on the evening preceding, and be allowed only liquids for the meal preceding. Subsequently to the injection, he should be allowed only liquids for the succeeding meal, and be retained under observation for at least twelve hours. Untoward symptoms following the injection are treated usually with epinephrin solution (0.6 to 1.2 cc.) or atropin.
Arsphenamines are administered intravenously, usually in the median cephalic or the median basilic vein at the bend of the elbow. This method requires aseptic technic throughout. All apparatus should be thoroughly washed before sterilization, since it is believed that symptoms may arise from substances extracted from glassware and rubber tubing. The water used must be distilled, preferably twice, and freshly boiled. The dose of arsphenamine is 0.3 to 0.6 gm., that of neo-arsphenamine is 0.3 to 0.9 gm. Until tolerance is ascertained, the dose should be small and not repeated in less than a week.
Neo-arsphenamine
1. Only a single ampule should be dissolved at a time. The powder should be dusted over the surface of a small portion of the water and permitted to dissolve without agitation. The solution is then made up to bulk. Specimens which do not dissolve readily are to be rejected.
2. Cold water only is to be used.
3. The solution should not be stronger than 0.1 gm. of the drug in 2 cc. of water.
4. A very small needle should be used, and the time of the injection should not be less than five minutes.
Arsphenamine
1. Cold Water Should be Used in all Cases.—(Exception. “Arsenobenzol” requires hot water. Consult instructions issued by individual manufacturers for possible departures from these directions.)
2. Neutralization and Alkalinization of the Solution.—With a graduated pipette or burette add 0.9 cc. of normal NaOH, standardized against normal acid, for each 0.1 gm. of the drug. The alkali should be added all at once, the amount specified being slightly in excess of that required to redissolve the flocculent precipitate first formed.
3. Concentration of the Drug.—It is important that the concentration of the drug is not greater than 0.1 gm. to 30 cc., i.e., 180 cc. of water for the usual dose of 0.6 gm.
4. Method of Injection.—The gravity method only should be employed. When several patients are to be injected from the same solution, the container for the solution should be graduated. A glass stopcock is of value in controlling the flow of solution, but in its absence the rate of injection can be governed by the elevation of the fluid and by the size of the needle. A needle of 18 or 20 B. & S. gauge is best.
5. Rate of Injection.—Operators should pay particular attention to the rate of administration since it is believed that rapidity of injection accounts for more unfavorable results in the use of arsphenamine than any other one thing. In no case should the rate exceed 0.1 gm. of drug (30 cc. of solution) in two minutes, i.e., twelve minutes for the average dose of 0.6 gm.
CHAPTER V
YELLOW FEVER
Definition and Synonyms
Definition.—Yellow fever is an important epidemic disease of the West Coast of Africa and tropical America caused by a spirochaetal organism, Leptospira icteroides. The spirochaete is contained in the peripheral blood only during the first three days of the disease. A mosquito, Stegomyia calopus (Aedes calopus), biting a patient during this period of his illness, takes in the organism which undergoes some developmental cycle of the nature of which we are ignorant, but we do know experimentally that a minimum period of twelve days is requisite for the completion of the cycle which makes the mosquito infectious for man.
When a susceptible individual is bitten by an infected mosquito there develops, after a period of incubation of from two to five days, a rapid rise of fever, with markedly congested face and severe pains of back and head. About the end of the third day the sthenic manifestations are succeeded by asthenic ones in which jaundice, haemorrhages, particularly black vomit, and anuria are the important features.
Faget’s sign of a lack of accordance between pulse and temperature is of great diagnostic importance.
Synonyms.—Febris Flava, Typhus Icteroides. Spanish: Fiebre Amarilla, German: Gelbfieber, French: Fièvre Jaune.
History and Geographical Distribution
History.—It would seem probable that yellow fever was the disease from which those of Columbus’ second expedition suffered in San Domingo, in 1495. At the same time the first definite description of the disease was that of Dutertre, in Guadaloupe, in 1635. There has been much discussion as to whether the West Coast of Africa may not have been the original endemic centre and the importation to the West Indies the result of the slave traffic. While there is very little support given this view the recent recognition of the extent and importance of the African endemic area, as brought out by Boyce, is somewhat suggestive. Spinden advances evidence to show that a devastating epidemic disease, attended with bleeding from[98] the mouth and nose, raged among the Mayas and Aztecs in pre-Columbian periods. One such epidemic is recorded as of 1454. There have been numerous severe outbreaks in the United States, that occurring in Philadelphia, in 1793, being the most celebrated and that centering in Memphis, in 1878, probably the most terrible. Yellow fever has been a scourge in Brazil since its introduction in 1849, until quite recently. Lisbon experienced severe outbreaks of the disease in 1723 and in the next century in 1850 and 1856. Many of the Spanish cities have also suffered from time to time.
The history of the connection between yellow fever and the mosquito is discussed under etiology.

Geographical Distribution.—As will be seen from the chart the chief epidemic centers are the islands and coasts of the Gulf of Mexico and the West Coast of Africa. The disease has at times extended down the West Coast of South America and is now rather prevalent in Ecuador. The last epidemic in the United States was that in New Orleans.
The disease has never invaded Asia or Australia and there is fear that the opening of the Panama canal may bring this about.
Guiteras, who has recently returned from an investigation of the problem of yellow fever on the West Coast of Africa, was unable to find evidence of its existence there at the present time. He notes an absence of the extreme heat and abundance of mosquitoes which are features of yellow fever ports of South America.
Etiology and Epidemiology
Etiology.—It is now generally accepted that the cause of yellow fever is a spirochaete, Leptospira icteroides, which is very similar to but slightly smaller than L. icterohaemorrhagiae of infectious jaundice.[99] Noguchi injected 74 guinea pigs with about 5 cc. of blood from 27 cases of yellow fever. The blood from 6 of these cases proved infectious, producing in 8 guinea pigs fever, conjunctival injection, albuminuria, a leucocytosis followed by leucopenia and, after a few days, a subsidence of the fever to normal or subnormal. At this time jaundice and haemorrhages occurred.

Fig. 41.—Dark-field view of Leptospira icteroides in a culture 16 days old. × 1000. (After Noguchi.)
Autopsies of the guinea pigs showed a fatty and yellow liver with nephritis. Some of the injected guinea pigs showed only fever but seemed to have acquired an immunity to subsequent injections of a virulent virus. In the blood, liver and kidneys of the animals showing the jaundice and albuminuria Noguchi was able to demonstrate spirochaetes by dark-field illumination. He also obtained cultures from such animals. Leptospiras were demonstrated in the blood of 3 out of 27 human cases but only after prolonged search. Cultures have been obtained from human yellow fever blood. For culturing, a medium is used consisting of 1 part of serum and 3 parts of Ringer’s solution made semisolid with 0.3% agar and contained in tall tubes. One cc. citrated yellow fever blood is introduced into the lower part of the medium. A thin layer of liquid petrolatum is poured on the top of the medium. We need partial oxygen tension but not anaerobiasis. Optimum growth temperature is 33°C. L. icteroides is from 4 to 9 microns long by 0.2 wide and tapers gradually to extremely thin sharp points. These organisms will pass the pores of V and N Berkefeld filters thus placing them in the group of filterable viruses. The virulence of different strains varies, with some strains as little as 0.00001 cc. of culture proving fatal for guinea pigs. Monkeys, rabbits and birds were not susceptible to infection but the marmoset and puppy seemed to respond as did the guinea pig.
By having Stegomyia (Aedes calopus) feed on infected guinea pigs as well as the human case of yellow fever, and subsequently allowing these mosquitoes to bite normal guinea pigs, the disease was transmitted[100] in a few cases. In certain infected mosquitoes Noguchi found leptospiral organisms with dark-field illumination. Mosquitoes fed on infected guinea pigs became infectious in 8 days, this shorter period over human feedings being due, probably, to the greater abundance of organisms in the blood of the infected guinea pigs over human yellow fever blood.
Guiteras doubts the etiological relation of Noguchi’s leptospira to yellow fever on the ground that in view of the susceptibility of animals to this organism the disease should exist as an epizootic, which is improbable in view of the ease with which yellow fever is eradicated when measures applied solely to man and the mosquito are practiced. Among other points of objection he notes the recovery of the spirochaete from the blood later than the third day of the disease.

Infection by Injection of Blood.—The subcutaneous injection of as little as 0.1 cc. of the blood of a yellow fever patient in the first three or four days of the disease, or the serum of this blood, which has passed through the pores of a Chamberland filter (F but not B according to the French Commission), will bring about the infection of a susceptible person after an incubation period of from one day and fifteen hours to twelve days and eighteen hours.
In the natural method of transmission the mosquito, Stegomyia calopus, is the intermediary. In order that the female of this culicine species may transmit the disease it is necessary that she bite a yellow fever patient in the first three days of his illness, after which a period of approximately twelve days must elapse before the mosquito can transmit the disease. In such case the period of incubation varies from two days one hour to six days two hours. Carroll was bitten by a mosquito which had fed on a yellow fever patient twelve days previously, and four days later experienced a very severe attack, this fact being against the views of the French[101] Commission that the disease shows a less severe form in those who may be bitten in the first period of the infectivity of the mosquito. A second case bitten five days later by the same mosquito that infected Doctor Carroll had a mild attack. Persons bitten by experimentally contaminated mosquitoes before an interval of twelve days had elapsed escaped infection.
Prior to the investigations of the American Commission our views as to the incidence and spread of yellow fever were chaotic.
Rush, in 1793, thought that the Philadelphia epidemic originated from “damaged coffee which putrefied on a wharf near Arch Street.”
In 1883, Doctor Friere reported that yellow fever was caused by a coccus, Cryptococcus xanthogenicus and claimed that he could confer immunity by vaccination with attenuated cultures. Carmona y Valle of Mexico and Carlos Finlay of Havana considered that the Micrococcus tetragenus was the cause but Sternberg, investigating these claims, showed that these cocci had nothing to do with yellow fever. In his work Sternberg isolated an organism which he designated “X.”
Bacillus Icteroides.—In 1897, Sanarelli isolated an organism which he named Bacillus icteroides. In investigating this organism Reed and Carroll found that it was closely related to the hog cholera bacillus. Certain American investigators substantiated the claims of Sanarelli. Sternberg, however, doubted these findings.
To further investigate the relation of B. icteroides to yellow fever Army surgeons were sent to Cuba in 1900.
American Commission.—In addition to Reed and Carroll, Lazear and Agramonte were also members of the Commission.
The Commission first cultured the blood of 18 yellow fever patients with negative results for B. icteroides in every case.
B. icteroides grows as readily on culture media as does the typhoid organism.
It was also shown that yellow fever blood, which was negative for B. icteroides, could produce yellow fever when injected subcutaneously. In 11 autopsies made shortly after death cultures from various viscera were negative for B. icteroides. It was then decided to abandon, as fruitless, further investigations as to Sanarelli’s organism, and to take up the mosquito transmission theory.
Mosquito Transmission.—In 1848, Doctor Nott, of Mobile, strongly advocated the insect transmission of yellow fever but not specifically incriminating the mosquito.
Riley from a study of Nott’s original paper, thinks that the author had in mind invisible forms of insect life, which could act as disease producers, and simply cited the mosquito to illustrate his views. In 1853, Dr. Beauperthuis, in Guadeloupe, noted that malaria and yellow fever ceased to exist in regions which from their altitude fail to nourish “insectes tipulaires.”
He also thought that the virus of these diseases was introduced by the channel of insect inoculation. Furthermore he stated that the variety, zancudo bobo[102] (Stegomyia), had white stripes on the legs and was in a way the domestic species. However, there is a question whether his zancudo bobo was Stegomyia and furthermore if we translate the expression inoffensif as without result it would negate the connection between this mosquito and disease production.
From 1881 Doctor Carlos Finlay had been advocating the transmission of yellow fever by Culex fasciatus (Synonym for Stegomyia calopus).
In 100 experiments made by Finlay 13 cases of yellow fever developed.
In no instance had these experimental mosquitoes fed on a yellow fever patient more than six days previous to their biting and, knowing that a period of at least twelve days must elapse, the infections in the 13 cases could not have been brought about by these experimental mosquitoes.
Extrinsic Incubation.—An observation by Carter influenced the Commission in their investigations. Carter, in 1898, noted that a period of about two weeks generally elapsed between the appearance of the first case and the group of cases resulting from this first case. He termed this period the “extrinsic incubation” and we now know this as synonymous with the twelve-day period of incubation in the mosquitoes infected by the first case plus the two to five days of the period of incubation in man.
The American Commission obtained ova from Doctor Finlay and from these ova mosquitoes were hatched for the experimental work. Of 11 susceptible persons, bitten by contaminated mosquitoes, the first 9 remained uninfected while the two volunteers, bitten subsequently (Aug. 27 and 31), developed the disease. One of these cases was that of Doctor Carroll, whose infection was brought about by one of these laboratory reared mosquitoes which had fed on 4 cases of yellow fever, two of which were severe cases and two mild. This mosquito had fed on one of the severe cases just twelve days previously. The other case was bitten by 4 contaminated mosquitoes, one of which was the one that had infected Doctor Carroll.
Of the 9 negative cases 6 were bitten by mosquitoes which had fed on yellow fever patients from the fifth to the seventh day of the disease and the remaining 3 failures were where the interval between contamination and biting the volunteer was from two to six days only.
At this time the medical mind was obsessed with the idea that yellow fever was transmitted by fomites.
It had been forgotten that Cathrall, in 1800, had failed to infect himself with black vomit and that Ffirth, in 1804, in order to obtain material for a graduation thesis, swallowed black vomit and smeared it, as well as blood, upon wounds he had made on his skin with negative result. (It will be remembered that the fourth proposition of the French Commission was that application of infectious serum to the abraded skin would not produce the disease—the hypodermic injection being required.)
Fomites.—To settle the question of the relative importance of fomites and infected mosquitoes the Commission caused two houses, 14 × 20 feet, to be erected, one well ventilated for the infected mosquitoes[103] and the other poorly lighted and ill ventilated for the black vomit contaminated clothes, sheets and blankets (fomites). A medical officer and two privates of the Hospital Corps slept in this room for twenty days in most intimate contact with the infected material. No infections resulted.
There were other experiments with similar results.
One of the occupants of the fomites building was afterward inoculated subcutaneously with 2 cc. of blood taken from a patient in the first day of the disease and developed yellow fever after four days of incubation. This proved that he was susceptible to yellow fever.
Blood from this patient, taken in the first three days of his attack, was injected into a third man who also developed yellow fever. This experiment was to prove that the production of the disease was due to a virus capable of multiplying rather than to a toxin. Of course, it would be impossible to conceive of a toxin so potent that it could produce symptoms in a third man when diluted in the circulation of the second man.
In the other building there was a screen partition dividing the space into two compartments, one containing 15 contaminated mosquitoes, the other with the same air but without mosquitoes. Controls occupying the mosquito free section remained free from yellow fever, while those exposing themselves in the mosquito-containing compartment developed yellow fever. One of these cases was bitten by mosquitoes contaminated thirty-nine days previously, a second one with fifty-one day insects and a third, who developed a severe case, was bitten by mosquitoes contaminated fifty-seven days previously.
As above stated the Commission inoculated men subcutaneously with blood, taken from yellow fever patients in the first three days of the disease, with positive results. It was also found that if the blood was heated to 55°C., for ten minutes the virus was destroyed and, finally, it was found that the filtrate from a Berkefeld filter was infectious, thus showing that the virus was so minute as to pass through the pores of a filter which would hold back the smallest known bacterium (filterable virus).
Experiments of Guiteras.—During the summer of 1901 Doctor Guiteras, with a view to immunity production, repeated the experiments of the Army Commission and infected 8 persons, 3 of whom died. Gorgas thinks the greater severity of these infections may be explained by greater virulence of the virus developing in the mosquito during the hot season. It is known that the development of this virus requires fifteen to twenty days in winter as against the twelve days for summer.
Note.—Doctor Lazear, who had charge of the mosquito work of the Commission, tried to infect himself with experimental insects prior to his applying a twelve-day mosquito to Doctor Carroll. About three weeks later he was bitten by a mosquito which he did not at the time consider a Stegomyia. The attack of yellow fever which resulted from this bite ended fatally.
To summarize, the American Commission found:
1. That B. icteroides had nothing to do with yellow fever.
2. That fomites was a negligible factor.
3. That Stegomyia calopus, when fed on the blood of a yellow fever patient, in the first three days of the disease, became contaminated and, after a period of twelve days, but not before, was capable of transmitting the disease to a susceptible person. Once infectious the mosquito so remained for the rest of life.

Fig. 43.—Aedes calopus (Stegomyia calopus), female. From P. H. Reports.
Fig. 44.—Aedes calopus (Stegomyia calopus), male. From P. H. Reports.
4. The blood of a yellow fever patient in the first three days, which was sterile for B. icteroides, was capable of producing the disease when injected subcutaneously. If heated to 55°C. for ten minutes the virus was destroyed however. Furthermore, infectious blood when passed through a Berkefeld filter remained infectious, thus showing that the virus is a filterable virus.
The French Commission verified these findings and in addition brought out the following points.
1. Cutaneous vaccination with infective serum is without result.
2. Infectious serum loses its yellow fever-producing power in forty-eight hours unless preserved under liquid petrolatum when it remains virulent for five days.
3. Infectious serum if heated for five minutes at 55°C. loses its virulence but has prophylactic and curative power.
4. Besides the method of hypodermic inoculation yellow fever can only be transmitted by the bite of a mosquito in which the virus has remained for at least twelve days.
5. In one instance it was thought that the progeny of infected mosquitoes transmitted the disease. Rosenau and Goldberger, in 38 experiments, failed to obtain such result.
Paraplasma flavigenum.—In 1909, Seidelin reported certain minute protozoa as existing in the red cells of yellow fever patients. He considered them as related to the piroplasms and gave the name Paraplasma flavigenum. It is stated that the parasite has been found as late as the fourteenth day from the onset of the attack. The idea is advanced that there may be carriers of yellow fever. These claims are generally denied.
Epidemiology.—There are numerous records which attest the almost universal susceptibility to yellow fever. In the Orwood epidemic, Carter has reported that of 46 persons entering an infected house, “Gray Mansion,” 45 contracted yellow fever.
On the “Lombardia,” with a complement of 249, there were 242 cases and 134 deaths. The 7, who escaped, were immunes.
The idea that the colored race possesses immunity is now thought to be connected with the contraction of the disease in infancy or childhood, attacks at this period of life being very mild and difficult of diagnosis.
Immunity.—As proof that such immunity is not racial we may note that in Ecuador the natives of the endemic area about Guayaquil possess an immunity due to mild attacks in childhood, but the natives of Quito, 300 miles distant, where there is no yellow fever, do not possess it, and many residents of Quito have contracted the disease when passing through Guayaquil to take steamer to Europe.
There has been some inclination to question the immunity conferred by an attack of yellow fever but Carter has shown that in quarantine practice we can admit such immunes with perfect safety. Thirty thousand such immunes were allowed to enter Key West and Tampa from Havana between 1888 and 1898 and no case of yellow fever developed from them. During the same period 450 non-immunes from Havana gave 13 cases in the quarantine stations.
The Yellow Fever Mosquito.—A knowledge of the life history of Stegomyia calopus explains the epidemiology of yellow fever. This culicine species is widely distributed in the tropical and subtropical world, extending from 38° north to 38° south latitude. It is rarely found at a greater altitude than 3000 feet. Petropolis, a railway-connected suburb of Rio, has an altitude of 2300 feet, with cool nights, at times about 9°C, and a freedom from Stegomyia. Persons having occupation in Rio during the day but returning to Petropolis in the afternoon escape yellow fever. In[106] this connection it is generally accepted that the female Stegomyia only bites between 5 o’clock P.M. and midnight. While the first feeding may occur earlier in the day, all subsequent feedings, which alone could be infectious, occur late in the afternoon or at night. (Recent observations show Stegomyia to bite in daytime,—not at night.)
These views, which were advanced by Marchoux, would explain the apparent freedom from infection of those leaving infected areas by the early afternoon. Seidelin, however, claims that these mosquitoes will continue to bite in the day after numerous feedings of blood.
It is recognized that railways are unimportant factors in transporting these mosquitoes, differing in this respect from ships which offer better conditions.
The Stegomyia is preëminently a house mosquito and a town mosquito. It is the domesticated one, while the malaria-transmitting ones are rural and feed in natural plant-containing bodies of water instead of the water in old tin cans, roof gutters, cisterns or other utensils surrounding the house which are preferred by the yellow fever mosquitoes.
Stegomyia seem to prefer water for breeding that is slightly tainted with sewage, although developing equally well in fresh water. They will also develop in brackish water.
When once this mosquito takes up its residence in a certain room of a house it rarely leaves it and thus is explained the danger of occupying a room which has been occupied by a yellow fever patient. Then too, the warning sound, so characteristic of the approach of most mosquitoes, is not given by Stegomyia.
The female lays about 70 eggs in small groups and not in a compact egg raft as with Culex. The eggs are therefore difficult of detection. The eggs do not suffer after rather prolonged drying. Even temperatures approximately 0°C. do not seem to destroy the viability. It would seem probable that it is this stage in the metamorphosis of Stegomyia which is responsible for the survival of the species under unfavorable conditions.
The eggs the American Commission received from Finley had been deposited thirty days previously on the edge of some water in a basin. The water had meanwhile evaporated and the eggs were dry. Notwithstanding this the eggs promptly hatched out when water was poured in the basin.
The most favorable temperatures for these mosquitoes range from 29° to 31°C. Under 20°C. the eggs do not hatch out.
The larvae, which hatch out in about two days, develop into pupae in approximately one week. In about two days the fully developed insect breaks out of the pupal case. It will thus be seen that a period of ten to fourteen days suffices for a generation. The insect is almost black and has a silvery lyre or Jew’s harp pattern marking on the thorax. The legs and abdomen also have silvery bands. The female lays several batches of eggs and has been observed in one instance to live 154 days. The French Commission kept a female alive 106 days. They consider that life under normal conditions is much shorter in duration than in captivity. If deprived of water the adult insect only lives about five days. In a refrigerator, Guiteras was able to keep mosquitoes alive, without food or water, for eighty-seven days.
On fruit and sugar vessels the conditions for the development of Stegomyia are exceptionally favorable.
These mosquitoes are prone to remain in the same house where they have been feeding. Carter has pointed out that yellow fever rarely spreads more than 75 yards from an infected house so that it is improbable that infected mosquitoes fly, or are carried by the wind, any great distance.
The same authority has also noted that ships in Havana harbor lying about 400 yards from shore never become infected when the crew have not been ashore or where infected ships have not been anchored near by.
It is probable that they are carried aboard ships in connection with coaling or provisioning rather than blown aboard by prevailing winds.

Fig. 45.—Temperature chart of Yellow Fever. A, Mild case with recovery. B, Severe case showing the saddle-back temperature curve similar to that of dengue. C, Chart of fatal case of yellow fever.
Pathology and Morbid Anatomy
The toxic effects are chiefly borne by the liver and endothelial linings of the capillaries. The cloudy swelling of the liver cells obstructs the bile canaliculi, causing jaundice, and the more advanced fatty degeneration of these cells brings about disturbances caused by interference with the important liver functions. The degenerative changes in the endothelial cells lining the capillaries bring about the haemorrhages so much a feature of yellow fever.
The icterus is apt to be more marked after death, and is especially prominent about the neck and eyelids. Dutroulau considers the absence of icterus in a cadaver as negativing yellow fever.
The liver is of a boxwood or chamois skin color and on section is very oily. Haemorrhagic patches may be seen dotting the yellow cut surface.
A midzonal fatty degeneration of the liver cells may be noted in cases dying by the 4th and 5th day but later there is degeneration of the entire lobule.
The stomach and intestines contain disintegrated blood. Petechiae and erosions are common in the cardiac end of the stomach. The upper part of the duodenum shows changes similar to those seen in the stomach but the other portions of the intestines are essentially negative.
The spleen does not show any particular change. The kidneys are enlarged, congested and on microscopical examination show fatty degeneration of the renal epithelium.
The adrenals often show fatty degeneration, especially of the cortex.
Haemorrhagic infiltrations are marked features in skin and mucous and serous membranes.
Symptomatology
A Typical Case. Sthenic Stage.—With very slight or absent prodromata, often during the night, the disease sets in rather abruptly with chilly sensations and the temperature rapidly rises to about 104°F. The face is flushed, dusky and swollen, the eyes injected. Very severe frontal and orbital headaches with marked rachialgia of the lumbo-dorsal region are peculiarly characteristic. The pulse is of high tension and the rate from 90 to 110. The systolic pressure is increased—at times as high as 175. These are the early manifestations of the first or sthenic period of the disease.
Vomiting, first of mucus and bile, comes on very early. About the second day albumin appears in the urine and by the 3d or 4th day this is present in large amount and is associated with the presence of hyaline and granular casts. The temperature remains fairly high for three or four days, with morning remissions and evening exacerbations. Of great diagnostic value is Faget’s law as to lack of correlation of temperature and pulse, in that by the 2d day, notwithstanding the high temperature, the pulse rate becomes less and by the 3d or 4th day it has probably decreased 20 to 40 beats from its initial rate.
Stage of Remission.—About the close of the 3rd day or upon the 4th day there may occur a fall in the temperature and a decided amelioration of the symptoms. This however is frequently not noted and even when present may last only for a few hours. It is often called the stage of remission or calm. By the 3d day the congestion of the facies and other sthenic manifestations have disappeared and, possibly preceded by the short period of remission, there is ushered in the second or asthenic stage.
Asthenic Stage.—It is at this time that we have the appearance of the most characteristic features of yellow fever—the jaundice and the haemorrhages. The jaundice is first noted in the sclerotics and rapidly spreads over the body as a lemon[109] to orange yellow tinging. Swelling and bleeding of the gums are the earliest signs of the damage to the capillaries. This may go on to bleeding from the nasal mucosa, the intestines and, best known and most dreaded, the coffee ground vomiting or black vomit of gastric haemorrhage. Epigastric tenderness is often marked. In very severe cases haemorrhagic extravasation into the skin may appear. The mind is peculiarly clear, the patient alert and suspicious. At times patients may be delirious even to the extent of wild struggling to throw themselves out of bed.
In favorable cases the temperature rapidly falls to normal, associated with an unusually slow pulse rate, even below 45.
In the first few days there is a normal white count, with an increase in the percentage of the polymorphonuclears and later on an increase in the large mononuclears.

Besides the typical course we may have cases so mild that the albuminuria is insignificant and the jaundice and haemorrhages entirely absent. On the other hand we may have fulminating cases with jaundice and black vomit setting in by the end of the 3rd day and rapidly going on to a fatal termination.
Symptoms in Detail
The Temperature.—This rises abruptly, reaching its maximum by the 1st day. Very high temperatures are not a feature of yellow fever. There is nothing characteristic in the further course of the fever chart and it should be borne in mind that the so-called intermission is transient and deceitful.
General Appearance.—On the 1st day the face is swollen and congested. This florid congestion, which may extend down the neck to the upper part of the chest,[110] is more marked in yellow fever than in any other disease. The eyes are shining, the conjunctivae injected and there is photophobia.
About the end of the 2d day the facial congestion disappears to be succeeded by an earthy tinging and subicteroid tinting of the conjunctivae. The jaundice does not appear until about the fourth day. This may be noted somewhat earlier if one blanches the skin by pressure with a glass slide. Petechial eruptions may be prominent in the later stages. The jaundice is best seen at a distance of 5 to 6 feet.
The Circulatory System.—Of peculiar value in diagnosis is Faget’s law—a falling pulse rate with constant temperature or a constant pulse rate with a rising temperature.
A markedly slow pulse, between 40 and 50, is often recorded about the time of the period of remission.
It is interesting to note that the pulse of yellow fever made a great impression upon Benjamin Rush, who called it the indescribable or sulky pulse. The systolic blood pressure is high at first, but by the 2d day begins to fall, becoming quite low in the asthenic stage (even below 70 mm.) due probably to supra-renal involvement rather than to cardiac weakness.
Haemorrhages, especially from gums, nose and intestines, are common. Black vomit is the best known of these haemorrhages.
Blood Examination.—This has generally been considered as varying but slightly from normal findings.
Noc states that in the first stages of the disease there is an increase of the polymorphonuclear percentage with a marked diminution or disappearance of eosinophiles while later on, from the 3d to the 6th day, there is an increase in the large mononuclears.
The Alimentary Tract.—The tongue may be coated in the center. Vomiting often appears early and consists of whitish or bile-stained mucus. It must be remembered that if black vomit should appear it almost never comes on before the 4th day. There is usually marked epigastric tenderness. Bleeding from the gums and intestinal canal are not rare.
The Nervous System.—The mind is unusually clear, the patient often mentally alert and suspicious. There is often insomnia. The severe cephalalgia, often frontal or supraorbital, as well as the severe loin pains (coup de barre) are striking features. There may be a marked hyperaesthesia. A delirious state may be present.
The Liver and Spleen.—There is no special alteration in the size of either liver or spleen. There may be tenderness about the liver region. The jaundice of the asthenic stage is incident to the pressure of the swollen degenerating liver cells on the bile capillaries while the fatal issue is connected with the loss of the urea formation function. It has been claimed that an acidosis may occur. The spleen is not affected.
The Genito-urinary System.—Albuminuria begins to appear about the second day and tends steadily to increase in amount. Various types of tube casts, often bile-stained, are abundant. The urine shows neither bile nor blood cells except in the later stages of the disease. The reaction is very acid. It is of the utmost importance to note the quantity of urine voided, as scanty secretion, leading to anuria, makes for a very grave prognosis.
Diagnosis
The main points to consider in the diagnosis are: (1) the facies, (2) the severe cephalalgia and rachialgia, (3) the early albuminuria, (4) the epigastric tenderness, (5) Faget’s law of lack of correlation between pulse and temperature, (6) the absence of clouding of the consciousness, and finally the late appearance of the jaundice and haemorrhages.
Of the greatest importance is the history of the case as to recent whereabouts and associates. Also careful questioning as to prior attacks of jaundice or albuminuria related to hepatic or renal diseases. Influenza in its sudden onset and fever and pains has much in common with yellow fever. Weil’s disease is much like yellow fever.
The diseases with which yellow fever is most apt to be confused are:
Aestivo-autumnal Malaria.—In ordinary aestivo-autumnal malarial paroxysms the search for the malarial parasite is of great importance, although the finding of a malarial infection does not exclude yellow fever. Albuminuria is not a feature of tropical malaria.
In that type of tropical malaria known as bilious remittent fever the clinical picture is rather asthenic and bile pigment in the urine is an early feature. Again jaundice comes on fairly early and the slow pulse is absent. The spleen is enlarged and tender.
Blackwater Fever.—This is an asthenic disease with marked and very early jaundice. The haemoglobinuria (Blackwater) is pathognomonic. Splenic tenderness is marked.
Smallpox.—The early headache, backache and vomiting of smallpox may well confuse one before the eruption of variola appears.
Dengue.—This is probably the most difficult disease to diagnose from yellow fever. The facies, orbital pains and backache of yellow fever and dengue are similar. Dengue also shows a slowing of the pulse. The high blood pressure of the onset is not present in dengue. There is no albuminuria in dengue and there is a marked and early leukopenia with reduction of the polymorphonuclear percentage, which does not exist in yellow fever. The jaundice of yellow fever and the eruption of dengue do not show themselves until after the first three days.
Relapsing fever, typhus fever and plague have been considered by some authorities as possible of confusion with yellow fever.
Bilious Typhoid of Egypt.—In 1851 Griesinger described a disease he called bilious typhoid of Egypt in which there was a sudden onset with marked chill and rise of temperature in four or five hours to 103° or 104°F. Rachialgia and bilious vomiting were marked. There was splenic enlargement. The temperature fell on the fourth or fifth day with at about this time the appearance of icterus. Relapses were the rule and the mortality was very high.
Bone pains, especially about the knee, were common and severe. This disease is now considered a relapsing fever. It is this disease which affected the troops of Napoleon in Egypt and which was thought by some authorities to have been yellow fever. Others think it may have been epidemic jaundice.
Prognosis
This is bad with advancing years and possible lesions of liver or kidneys. It is difficult to make a statement as to the average mortality. Thus, in the epidemic of 1853, one of the most virulent that ever visited New Orleans, the mortality was estimated at 85%, while that of 1897, one of the mildest epidemics on record, only gave a mortality of ½%.
As a general rule the earlier in the year an epidemic starts the more virulent the disease; thus the 1853 epidemic, just referred to, started in May.
High temperatures and excessive albuminuria, as well as early appearance of jaundice, are bad signs. The mortality may be considered as averaging about 20%.
Prophylaxis and Treatment
Prophylaxis.—By screening a patient during the first three days of the disease we prevent the infection of Stegomyia (Aedes).
It must be remembered that this mosquito not only breeds near human habitations but that it tends to remain in the same room where it has been feeding. Consequently we should use sulphur fumigations or Giemsa’s spray or killing by hand to destroy insects. The larvae breed by preference in old tin cans near the house door. To kill these one should empty every old receptacle of water, and oil or cover other collections of water.
All receptacles used for collecting and storing water draining from roofs should be carefully screened with fine copper wire gauze. Of particular importance is it to treat every suspicious case as it if were one of yellow fever and screen the patient as well as destroy any mosquitoes in the room or house occupied by such patient.
Noguchi reports success in prophylaxis by the injection of 2 cc. of a killed culture of Leptospira icteroides. Immunity is not conferred until after the tenth day. He notes that among 3607 persons vaccinated in Salvador there were no cases of yellow fever while among the unvaccinated 181 cases occurred. Killed cultures of Leptospira icteroides were first used for protective inoculation in 1918 when 427 vaccinations were carried out.
Treatment.—At the onset one should give calomel in small doses, repeated every twenty minutes, until about 2 grains are taken, as 8 doses of ¼ grain calomel with soda. Magnesium citrate or sodium phosphate should follow the calomel. Some prefer castor oil in large doses (2 ounces). This treatment should not be repeated, it is only indicated at the onset of the disease, so that if the case is not seen until after the second day the laxative or purgative measures should be withheld.
During the first three days of the disease no nourishment whatever should be given. The patient should be allowed an abundance of fluid, of which the best is Vichy, of which may be given a couple of ounces every twenty minutes or so, iced or just[113] cool, as the patient prefers. Water, to which 30 grains of bicarbonate of soda to the pint has been added, makes a good substitute. It is of vital importance to put the patient to bed and keep him quiet. When vomiting is severe cracked ice or iced champagne may be of value. Alkaline enemata are indicated when the patient cannot retain the Vichy. There would seem to be an acidosis in yellow fever.
A mustard foot bath is best given in bed, the feet and legs of the prone patient being immersed in a foot tub half full of warm water into which a pound of freshly ground mustard has been stirred. Every few minutes there should be added a quart of very hot water so that the bath may be very hot—just short of burning the feet. The blankets are kept over the patient and the foot tub, so that we also give a vapor bath which causes free sweating. This treatment relieves the headache and backache. This foot bath can be repeated 2 or 3 times in the first twenty-four hours. After the bath, the sweating patient must be thoroughly dried. Cold spongings are important means of keeping down fever. For anuria use dry cups to the loins or hot fomentations. Strychnine may be indicated in the asthenic stage and camphor in oil hypodermically for extreme cardiac weakness. The Sternberg treatment is 150 grains of sodium bicarbonate and ⅓ grain of bichloride of mercury in a quart of water. The dose is 1½ ounces every hour.
Any exertion causing a rise in blood pressure may be fatal. It is possible that the stimulation of the circulation incident to the taking of food may explain the dangers of allowing food to a patient. As before stated no food should be given for the first two or three days. Then commence with albumin water and thin barley gruel. Later on wine jelly and easily digestible broths. Even when convalescence sets in we should be very careful as to diet.
Noguchi has produced an immune serum to his spirochaete by injecting horses. He has records of 170 cases of yellow fever treated with this serum with a mortality of 13.6%, while untreated cases gave a death rate of 52%. He notes that the serum must be given before the third day of the disease to be of any value—best results in the first day. He believes also that though salvarsan and neosalvarsan have some leptospiricidal action they are both too damaging to the kidney to supplant serum in treatment.
CHAPTER VI
INFECTIOUS JAUNDICE
Definition and Synonyms
Definition.—Infectious jaundice is a spirochaete infection, caused by Leptospira icterohaemorrhagiae. This spirochaete is a common parasite of rats in various parts of the world and man possibly receives his infection from this source. There is a sudden onset with rather high fever, headache and vomiting. The jaundice appears about the third or fourth day when the urine shows albumin and bile. Haemorrhages, especially epistaxis, are common and the liver rather than the spleen shows enlargement. A polymorphonuclear increase is a feature.
Synonyms.—Epidemic jaundice. Spirochaetosis icterohaemorrhagica. Typhus bilieux. Weil’s disease.
History and Geographical Distribution

Fig. 47.—Showing Leptospira. (After Noguchi in Journal of Experimental Medicine.)
Fig. 48.—A group of Leptospira icterohaemorrhagiae from a culture. (After Noguchi in Journal of Experimental Medicine.)
History.—This disease was probably the form of jaundice noted in the forces of Napoleon during the Egyptian campaign. It was first recognized as a distinct disease by Weil, in 1886, who described it as a peculiar form of acute infectious disease characterized by jaundice, swelling of spleen and nephritis. Inada and his Japanese colleagues discovered the causative spirochaete in 1915 and noted the frequency of this parasite in rats. Infectious jaundice was an important disease of the soldiers of the recent war.
Geographical Distribution.—Japan and Egypt may be considered as the parts of the world in which the disease is most common. It is endemic in West Africa and cases have frequently been reported from the shores of the Mediterranean.
During the Russo-Turkish war (1877) cases of jaundice seen in the Balkans by Sandwith were probably infectious jaundice as the disease was frequently noted in that region during the recent war. Cases were noted in Flanders during the war. A few cases have been reported from the United States.
Etiology and Epidemiology
Etiology.—The spirochaete causing infectious jaundice, Leptospira icterohaemorrhagiae, is the type species of a genus described by Noguchi as having minute elementary spirals running throughout the body and failing to show either flagella or undulating membrane. The caudal portion of the spirochaete is remarkably flexible and when in motion the whole body seems drawn into a straight line except for the hook formation of one or both terminal portions. Propulsion seems to occur by the rotary motion of the hook and progresses in the direction of the straight end. If both ends become curved progression ceases.

Fig. 49.—Four specimens of Leptospira icterohaemorrhagiae. (After Noguchi in Journal of Experimental Medicine.)

Fig. 50.—A leptospira viewed under the dark-field microscope. (After Noguchi in Journal of Experimental Medicine.)
It is insoluble in 10% saponin thus differing from the other blood spirochaetes. The constituent spirals are closely placed and the total length may reach 15 to 20 microns. The dark-field illumination is preferable for its demonstration although it shows up well by various staining methods. To culture use a medium of one part of rabbit’s serum with three parts of Ringer’s solution inoculating with citrated plasma. The organism is found in the blood during the first three or four days of the disease. It is also present in the urine. Young guinea pigs are particularly susceptible and in them we have, following injection of the blood of a case, jaundice, albuminuria and haemorrhages. At autopsy the spirochaetes are best demonstrated in a liver emulsion. Infection with this spirochaete is common among rats in various parts of the world so that it may be considered a natural infection of rats, but they do not seem to suffer from it.
Epidemiology.—It is considered that the infection is transmitted through the urine of infected rats or men. The spirochaetes may gain entrance through the skin or by mouth. The fact that the spirochaetes seem to die in urine within 24 hours makes infection by the contaminated urine questionable but experiments with various arthropods have failed to indicate their connection with the transmission of the disease.
In Japan it has been noted that the disease is most common in wet mines, disappearing when the mines are pumped dry. Before we knew the cause of the disease attention was directed to the connection between the infection and working about defective sewers. Trench warfare, with the accompanying rats and wet conditions, seemed to favor infection.
Pathology
The liver shows enlargement and fatty degeneration, but less marked than in yellow fever. The organisms are found in the liver and also in the kidneys, which latter show an intertubular congestion together with haemorrhages in this region. Haemorrhagic areas may be present in various portions of the alimentary tract and elsewhere.
Symptomatology
After an incubation period of from 5 to 7 days the disease sets in abruptly with rigors, headache, muscular pains and vomiting. The patient is prostrated and has the appearance of extreme illness; the face flushed and the conjunctivae injected. There is fever of an irregular type usually running between 102° to 104°F. for the first three or four days, when it begins to fall by lysis although occasionally by crisis about the fifth day. Following a few days of moderate fever or normal temperature there is a tendency for a second rise toward the end of the second week, which continues for approximately another week when a slow convalescence sets in in favorable cases. The secondary fever shows rather marked oscillations.
Jaundice appears about the third or fourth day with marked tenderness of the liver and slight or moderate enlargement of the spleen. The urine is scanty and high colored showing albumin and bile pigments. Early in the second week urine of a low specific gravity is excreted in large amounts. The pulse is rapid at first to become slow with the appearance of the jaundice. There is a tendency to sleeplessness and nocturnal delirium and in unfavorable cases the “typhoid state” comes on. Pains in the nape of the neck and calf muscles are common features.
Haemorrhages, starting as epistaxis, are commonly observed. Next to epistaxis[117] intestinal haemorrhage is the most frequent. Haematuria is rarely observed. The red cells and the haemoglobin fall in percentage with an increase in the polymorphonuclears. The leucocytosis runs about 15,000.
The spirochaetes may be found with the dark-field illumination early in the disease in a blood examination and later on in the urine.
Diagnosis
It must be remembered that the causative spirochaete is very scarce in the blood of this disease which is usually not the case with relapsing fever showing jaundice. It is best to inject 2 to 4 cc. of blood into young guinea pigs intraperitoneally and after the development of the infection in the animal we find the spirochaetes rather abundantly in preparations made from liver emulsions and examined with dark-field illumination. Noguchi cultured the organism from the blood early in the disease but found it difficult. Wataguchi states that when the blood is simply diluted with water and kept at a temperature of about 25°C. growth may be obtained by the fourth day, reaching a maximum by the second week.
Agglutinins appear in the blood about the end of the first week and cultures may be agglutinated by such serum diluted as high as 1 to 500.
Bilious remittent fever shows earlier jaundice, a more rapid pulse rate and malarial parasites.
In yellow fever there is more marked rachialgia and earlier and more marked albuminuria. The marked leucocytosis of Weil’s disease should be of differentiating value.
The early jaundice and haemoglobinuria of blackwater fever should distinguish this disease.
Prophylaxis and Treatment
Prophylaxis.—As the infection appears to be transmitted through the medium of the urine and faeces, sterilization of these discharges from those sick with the disease should be practised. Extermination of the rat, the host of the parasite, is the important method of eradication of the disease.
Treatment.—This would appear to be solely symptomatic. Arsphenamine has no effect on the infection. Hexamethylenamine has been recommended. A serum against the organism has been prepared and seems to show protective value.
CHAPTER VII
RAT BITE FEVER
Definition
Rat bite fever is a relapsing type of fever following the bite of rats infected with Leptospira morsus-muris, which brings about the infection of man with this spirochaete. Following the healing of the wound we have developing in the cicatrix inflammatory signs with lymphangitis and swelling of the tributary lymphatic glands. The onset is sudden with rigors and fever, which latter continues for several days to then fall to normal and after an apyrexial period to be followed by relapse. Numerous relapses follow during the following weeks, months or even years of the disease. In Japan the disease is known by the name of Sodoku.
Etiology and Epidemiology
Etiology.—In a study of this disease Futaki and others discovered a spirochaete in the tissues of the bite area and the adjacent lymphatic glands (1915). These spirochaetes were about 10 microns long. In the blood of man and infected animals shorter and thicker spirochaetes are found (3 to 6 microns). When cultivated in the media used for other Leptospira we have longer forms up to about 20 microns. The shorter forms are considered as young organisms.
Leptospira morsus-muris is found in the blood of infected mice, rats or guinea pigs during the first two weeks and then becomes distributed in the connective tissues especially that of the lips, bridge of nose and tongue. They are not secreted in the saliva but the transfer seems to occur by a break in the spirochaete-containing tissues and thus inoculated into the bite wound. The organism may possibly be excreted in the urine.
Epidemiology.—It has been found that about 3% of house-rats in Japan are carriers of the disease. It is less frequent in other countries although reported from various European countries, America and especially China. The disease has also been reported from Australia.[119] It seems probable that the construction of the Japanese houses gives greater opportunity for the occurrence of bites of rats than elsewhere.

Fig. 51.—Spirochaeta (morsus) muris in lung of mouse inoculated with blood from human rat bite fever. Silver impregnation. × 1500. (From MacNeal. After Futaki, Takaki, Taniguchi and Osumi.)

Fig. 52.—Spirochaeta (morsus) muris in blood of guinea pig with experimental-rat-bite fever. Giemsa’s stain. × 1250. (From MacNeal. After Futaki and associates.)
Pathology
In infected guinea pigs there is swelling of the lymphatic glands and the spleen with the presence of spirochaetes. The liver is congested and may show a few spirochaetes. In human autopsies there are degenerative changes in the liver and kidneys. The infection is rarely fatal in experimental animals although it causes about a 10% mortality in man.
Symptomatology
Following a rather long incubation period of from six to eight weeks, although cases have been reported where not more than two weeks had elapsed from the time of injury, during which time the wound of the rat bite heals, we have a rather sudden onset with headache, nausea and marked weakness. The cicatrix now becomes inflamed and the surrounding tissues show oedema and at times vesicle formation. Leading from the inflamed areas is a line of tender lymphatics which extend to a group of swollen lymphatic glands.
The onset is often characterized by chills and malaise. A rapid pulse and prostration are present during the pyrexial period.
The fever rises rapidly to 101°F. or 102°F. and within two or three days has reached about 104°F. and remains high for two or three more days. About this time it falls rapidly to normal, attended with profuse sweating. The temperature remains normal for a few days, during which time the local swelling and inflammation subside. An eruption of purplish spots may accompany the fever, appearing chiefly on chest and arms. There may be urticarial lesions. Joint pains, together with motor and sensory disturbances, may be noted.
Symptoms of nephritis may appear.
After the critical fall of temperature there is usually an apyrexial period of several days during which time the local manifestations about wound and glands subside. The fever again comes on, to later disappear and reappear.
The successive paroxysms are usually of less severity.
The fever is suggestive of the relapsing fevers. The pulse is rapid and weak. There may be as many as twelve of these febrile accessions and the course of the disease may extend over several months. There is an eosinophilia and during the febrile paroxysm a leucocytosis of about 15,000. The spirochaetes should be looked for in the blood during the early febrile periods. The dark-field illumination is the best method for their demonstration.
Treatment
Treatment is entirely symptomatic. Some success seems to have followed the administration of salvarsan.
Strychnine for the heart weakness and tonics during convalescence are recommended.
Aspirin is often necessary to relieve the headache and joint pains.
As prophylactic measures the same precaution should be taken as to cauterization of the wound as one would observe in rabies.
CHAPTER VIII
THE LEISHMANIASES
Definition and Synonyms
Definition.—Under this designation we group three diseases, two of which are general infections and one a cutaneous affection. It is now thought that the visceral leishmaniasis of adults or Indian kala-azar and that of young children or infantile kala-azar are one and the same disease. The cutaneous leishmaniasis of the Near East or oriental sore and the various leishmania ulcerations of tropical America are grouped with the others solely by reason of their cause, this being a protozoon of the same genus, Leishmania tropica for the skin leishmaniases, and L. donovani for the visceral ones. Most authorities assign to infantile kala-azar a distinct species, L. infantum.
The visceral leishmaniases are characterized by a chronic course, marked splenic enlargement, progressive anaemia and emaciation together with leucopenia. The cutaneous leishmaniases can only surely be differentiated from other tropical sores by the finding of the leishman bodies from smears made from the granulomatous tissue of the sore.
Synonyms.—Dum-Dum Fever, Tropical Splenomegaly (for Indian Kala-azar), Splenic Anaemia of Infants, Ponos (for infantile kala-azar), Oriental Sore, Biskra Button, Bagdad Boil, Bouton d’Orient, Aleppo Boil, Granuloma Endemicum (for the Eastern cutaneous leishmaniasis), Espundia, Bubas Braziliana, Uta, Forest Yaws (for the American cutaneous leishmaniasis).
General Considerations of History, Etiology and Relationship
History.—In 1869 the English medical authorities in India became familiar with a very fatal disease among the natives of Assam but regarded it as a very malignant form of malaria. The native designation for the disease was kala-azar. In 1889 Giles investigated this disease and finding hookworm ova in almost all of the cases he came to the conclusion that it was ancylostomiasis.
Rogers (1896) and Ross (1898) after studying the disease were of the opinion that it had to do with malaria, the former regarding it as a malignant form of malaria and the latter that it was malaria plus some secondary infection.
Owing to the very similar temperature charts and misled by agglutination tests of the serum of kala-azar patients, which he regarded as showing agglutinins for the Micrococcus melitensis, Bently, in 1902, claimed that kala-azar was a malignant form of Malta fever.
In 1903 Manson suggested that the disease might be caused by a trypanosome, the absence of malarial parasites and non-response to quinine being against the then usually accepted malarial etiology.
A few months later in the same year, May, 1903, Leishman reported findings which he considered as degenerated trypanosomes in the spleen pulp of a soldier who died in 1900 at Netley Hospital of dum-dum fever. Although first noting the peculiar bodies in 1900, at the time of making the autopsy, he was at a loss to explain their significance but in 1903, while examining a trypanosome-infected rat, he came to the conclusion that there was a similarity in the parasites of the two infections and published his paper entitled “On the possibility of the occurrence of trypanosomiasis in India.”

Fig. 53.—Leishmania donovani. Smear from juice after puncture of spleen of case of Indian Kala-azar. (MacNeal from Doflein after Donovan.)
In July, 1903, Donovan reported the finding of similar parasites in material from splenic puncture of cases of dum-dum fever and taken during life.
There was much discussion as to the true nature of these leishman, or leishman-donovan bodies, Laveran regarding them as piroplasms while others thought them to be trypanosomes.
In 1904 Rogers succeeded in cultivating these parasites in citrated salt solution and noted that the cultural forms were those of flagellates. In 1903, Wright, of Boston, found similar parasites in the granulation tissue of a tropical ulcer in a little Armenian girl.
In 1905, Pianese found leishman bodies in smears from liver and spleen of children dying with infantile splenic anaemia in Italy. About the same time Laveran in examining spleen smears made by Cathoire from an infant dying of an undetermined disease in Tunis found these bodies. Later investigations have shown this infantile[123] leishmaniasis to be rather prevalent in the Northern part of Africa and Southern part of Europe.
Quite recently it has been determined that not only is the classical oriental sore a form of leishmaniasis but, as well, certain skin ulcerations found in South and Central America, such as espundia and uta in Peru, bubas in Brazil and forest yaws in the Guianas.
Etiology.—The parasites which cause a general infection in kala-azar and leishmania infantile splenic anaemia but a local one in oriental sore are usually separated as distinct species, Leishmania donovani for kala-azar, L. infantum for infantile splenic anaemia and L. tropica for oriental sore.
These parasites are grouped with the haemoflagellates and occur in their vertebrate hosts exclusively as small, oval, cockle-shell-shaped bodies, measuring 2.5 × 3.0 microns. The protoplasm stains a faint blue and contains a rather large trophonucleus which is peripherally placed and gives the appearance of the hinge of the cockle shell. Besides this macronucleus we have a second chromatin-staining body which is often rod-shaped and set at a tangent to the larger nuclear structure. It is called the blepharoplast or micronucleus and stains a more intense reddish than the rather fainter stained pinkish macronucleus. One or more vacuoles are common in the cytoplasm.
Some consider these nonflagellated bodies, which are usually found packed in endothelial cells of spleen, liver, lymphatic glands and bone marrow, as resting stages, the flagellate existence occurring in some other host than its vertebrate one. Patton has carried on an immense amount of experimental work with the bedbug and has noted the development of flagellate forms from the 5th to the 8th days in bugs which fed on kala-azar patients showing leishman bodies in their peripheral circulation. If the bugs are allowed a second feeding after the infecting blood meal the flagellates disappear within twelve hours, so that for full development in the bedbug a single feeding is requisite. He states that the flagellate forms change to post-flagellate ones by the twelfth day. At the same time, although much evidence exists in favor of the bedbug as host for the flagellate forms, it has not been shown experimentally that the bedbug is definitely connected with the transmission of the disease.
Donovan is disposed to incriminate Conorhinus rubrifasciatus as the transmitting agent and furthermore he feels that there has not been sufficient investigation of mosquitoes along this line.
Canine Leishmaniasis.—In the regions where leishmaniasis of infants occurs there is also found a similar disease of dogs and Basile has claimed that the disease is transmitted from dog to dog by the dog flea. As the dog has been regarded by some as the reservoir of the virus, so naturally the transmission of the disease from dog to child through the flea has been considered.
Wenyon, however, tried to infect two young dogs with great number of fleas which had previously fed on dogs infected with canine leishmaniasis and at autopsy, five or six weeks later, was unable to find parasites in smears from spleen, liver or bone marrow and did not succeed in obtaining cultures from this material inoculated into tubes of N. N. N. medium.
Basile states that a temperature of 22°C. is necessary for the development of the parasite in the flea and that negative experiments have been due to their not having been conducted in the winter. Patton has had fleas feed on a heavily infected dog, whose peripheral blood showed hundreds of parasites per film. These experiments were made in the winter and although examining 200 of these fleas he failed to find any evidence of the flagellates after eight hours.
Views have been entertained that the canine infection is one with a flea herpetomonad distinct from Leishmania, but as dogs can be infected with L. infantum and then show manifestations similar to canine leishmaniasis the parasites are probably the same.
Patton fed great numbers of fleas on a dog experimentally infected with L. donovani and found that the flagellates had entirely disappeared from the alimentary tract of fleas dissected after eight hours, although fleas dissected within four to six hours showed degenerating Leishmania.
As regards oriental sore Wenyon has found that bedbugs and Stegomyia will feed from the sores and take up parasites which develop into flagellate forms in the gut of the insects.
Proof of transmission by these agents however is lacking and others are inclined to suspect the house fly or some species of moth midge.
In Brazil there exists some evidence that the cutaneous leishmaniasis found there may be transmitted by species of the tabanid family.
It must be understood that there is always a suspicion that the flagellate forms noted in arthropod experiments may be those of nonpathogenic herpetomonad or crithidial species as such forms are common in arthropods and are difficult to distinguish from the flagellate stage of leishman bodies.
Cultural Forms.—Very definite is our knowledge of the cultural forms of Leishmania. Rogers first cultured material from splenic juice of kala-azar patients in 10% sodium citrate solution at a temperature of 17° to 24°C. The medium was slightly acidulated with citric acid. There was no satisfactory development at blood temperature. In forty-eight hours the oval parasites have developed into herpetomonad flagellates, from 20 to 22 microns long by 3½ microns broad, with a 20-micron flagellum which takes origin from the blunt anterior end of the body near the blepharoplast. The peripheral blepharoplast and centrally placed macronucleus are at a distance from one another as opposed to the approximation of the crithidial blepharoplast to the centrally placed nucleus in a body with pointed anterior end.
Formerly it was thought that there were differences in the three species of Leishmania from the standpoint of growth on various culture media, L. donovani not growing on N. N. N. medium while L. infantum grew well on N. N. N. medium but not in citrated blood. It is now known that both species will grow on these two media.
It is absolutely essential in culturing L. donovani or L. infantum that the blood agar or citrated blood be sterile, as any bacterial contamination prevents growth. With the parasite L. tropica, however, bacterial contamination does not inhibit development and statements have even been made that growth is favored by a staphylococcal symbiosis. L. tropica, it would seem, will develop into flagellated forms in cultures at 28°C. while it will be remembered that Rogers in his original experiments failed to obtain other than commencing signs of division at 27°C., 22°C. being the temperature necessary for the development of flagellate forms.
L. tropica from South American cutaneous leishmaniases seems to grow more luxuriantly on N. N. N. medium than does that of oriental sore of Asia and Africa.
Giugni tried N. N. N. media made with human, rabbit and dog blood, respectively. The parasites grew well on dog and rabbit blood media but not on that made with human blood. He found growth best when he added salt in quantity from 5 to 9 grams per liter. When red corpuscles are laked in a medium the growth is less favorable.
While differences in development on different culture media may obtain not only with different species but with different strains of the same species, it would appear that such variations cannot be utilized as a means of separating the three species.
Animal Inoculation.—With animal inoculations we formerly thought that the parasite of kala-azar could be differentiated from that of infantile leishmaniasis by the fact that dogs could not be infected with L. donovani, while they were susceptible to infections with L. infantum. Recently Donovan and Patton have successfully inoculated dogs with kala-azar splenic material. Patton found the parasites in the liver, spleen and lymphatic glands as well as bone marrow of the inoculated dogs. Consequently we cannot separate the two visceral leishmaniases from a standpoint of susceptibility of the dog. Monkeys are susceptible to both diseases. It is important to recognize the fact that animal inoculations, even with spleen-juice, rarely give rise to infection.
As regards separating oriental sore from the visceral leishmaniases Gonder has shown that white mice may be infected with both kala-azar and oriental sore, there being produced in each case a general infection with the presence of parasites in spleen and liver. A point of difference, however, is that the oriental-sore mice develop lesions on feet, tail and head which was not observed with the kala-azar mice. There are some reasons for thinking that in human cutaneous leishmaniasis a generalized infection may precede the local manifestations.
Dogs and monkeys can be infected with L. tropica as well as mice, but in them we have only cutaneous lesions produced. Inoculation should be made intraperitoneally.
A very interesting point is that the dogs in India never show a natural infection with L. donovani, while in the regions where L. infantum is responsible for human infections the natural infection of dogs is not uncommon, indeed many think the dog the reservoir of virus for both L. infantum and L. tropica. It has been suggested that the dogs of India, where kala-azar prevails, may be immune.
Morphology.—As regards morphology it is usually stated that the parasites of the three species of Leishmania are practically identical. In cultures it has been noted that the flagella of L. tropica are longer and more twisted than those of L. infantum. Again it has been observed that the parasites of the Oriental and South American skin lesions may at times show a flattened or band-like trophonucleus instead of the constant round or oval one of the visceral leishmaniases.
Escomel has reported the finding of flagellated Leishmania in the South American sores.
Relationship.—Within the past year the view has been generally accepted that Indian kala-azar and infantile kala-azar are one and the same disease, the points of difference between L. donovani and L. infantum which had been advanced from cultural and animal inoculation standpoints having been disproved.
It has been suggested that the Mediterranean basin may have been the original focus of visceral kala-azar and that it spread thence to India by way of Greece and the Russian Caucasus, cases having been reported from districts which would join the two foci.
Just as children bear the brunt of malaria in old malarious districts and adults suffer in places in which the disease has been more recently imported, so by analogy we may consider the disease as of more recent introduction in India. We now know that visceral leishmaniasis is widely distributed in China, north of Yangtse, as well as in the Sudan, and quite recently a case of kala-azar has been reported from South America, in an Italian, who had lived in Brazil from 1897 to 1910.
In the Mediterranean basin there is a natural canine leishmaniasis and some think the human form may be contracted from the dog through the medium of the flea. This dog kala-azar exists in two types, one acute and the other chronic.
Some entertain the view that the virus of oriental sore is that of a modified visceral leishmaniasis and there has been experimental work along the line of determining whether the cutaneous infection immunized against the visceral or vice versa as with vaccinia and small pox.
Manson has suggested that as oriental sore is common in camel-using countries it might be that a passage through the camel lowered the virulence of the parasite as passage through the bovines does variola, so that such an infection was of a mild type.
More recently there has been some evidence to indicate that oriental sore may simply be a manifestation of a visceral infection as shown in Gonder’s work with mice and from the fact of the long period of incubation in oriental sore with the appearance in some cases of general symptoms as well as the cutaneous ones.
The South American leishmaniases differ clinically from oriental sore in that, following the primary lesions, ulcerating granulomatous processes of nasal and buccal cavities frequently set in subsequently, at times even after the primary manifestations have healed.
Visceral Leishmaniasis
General Considerations.—There are two types of kala-azar, as the visceral leishmaniasis is termed, one the Indian kala-azar, which prevails in Assam, Madras, Indo-China, China and the Sudan and characterized by a subacute or chronic febrile course and splenomegaly in older children or adults and the other, the infantile type, which in over 90% of cases occurs in children under four years of age.
In 195 cases reported from Assam, by Mackie, 100 were in children between six and ten years of age so that it is hardly true to call Indian kala-azar a disease of adults.
The infantile type, which occurs chiefly in the countries bordering the Mediterranean, is usually stated to be caused by Leishmania infantum while the adult type is said to be caused by L. donovani. If, as is now thought, the two parasites are identical it will be necessary to drop the name L. infantum.
Epidemiology.—Whether Indian kala-azar is transmitted by the bedbug or infantile kala-azar by the flea are points which have not been experimentally proven. It must be admitted that epidemiological evidence supports the bedbug transmission view for the former.
On the other hand, Mackie dissected 322 bedbugs which he had fed on kala-azar cases with practically negative results. He also injected material from 588 bugs into two monkeys with negative results. Mackie was likewise unsuccessful with lice, mosquitoes and sand flies.
Rogers, investigating the disease in Assam, found that the usual history in the villages was that someone with the disease came to a village and subsequently other cases appeared. It was shown that where a village escaped while others near at hand suffered there was a history of nonintercourse with the infected villages. The natives took extreme steps to eradicate the infection, it having been reported that the Garos even burned the patients as well as their huts. All evidence shows that the infection is contracted by sleeping in an infected house. House epidemics and family epidemics are often noted.
At the same time various observers have frequently noted instances where an advanced case may associate intimately with his relatives for months or years and yet none of these develop the disease.
There is little to support the view that it is a contact infection, as such does not occur in hospitals where verminous insects are absent. By isolating the sick and moving the uninfected to new houses, only a short distance away, there is no spread of the disease. The disease practically appears only in those Europeans who live with or among natives.
In view of the fact that Leishmania may be found in the intestinal ulcerations or in the kidneys there have been suggestions that the disease may be spread through the medium of faeces or urine. There is not the slightest evidence that the parasites could live in water which they might contaminate and the view that some sort of transmitting host might take up parasites from the faeces or urine is improbable, as the parasites have never been found in faeces or urine.
The fact that a distance of 300 yards seems to suffice for permanent protection of the uninfected excludes from consideration such transmitting agents as the mosquito or house fly.
The tendency of some to incriminate soil factors can be explained by the well-known fact that bedbugs can live for months without food, being ready to bite those entering an infected house even after long disuse as a habitation of man.
Infantile kala-azar may possibly be connected with the disease in dogs and may be transmitted by the agency of the flea but there is nothing like the evidence for this view that obtains for the bedbug theory in Indian kala-azar.
Pathology.—At autopsy there is noted marked emaciation with greatly enlarged spleen and liver, dropsical effusions and ulceration of the large intestine. The spleen is often enormously enlarged, rather firm but quite friable. The liver may at times show cirrhosis but the usual change is a distention of the endothelial cells of the intralobular capillaries with great numbers of parasites, as many as 100 or more parasites being at times found in a single cell. Not only do the endothelial cells of the liver contain parasites but those of the spleen, particularly the cells lining the venous sinuses as well as those of the pulp cords, the lymphatic glands and bone marrow. The parasites are present in the intestinal ulcerations of the terminal stages. Less frequently they are found in kidneys, adrenals, testicles, pancreas and lungs. Rarely, parasites may not be found at the autopsy of advanced cases. It is possible that the finding of coccus-like bodies in the cells of such cases may represent degenerated leishman bodies. The mesenteric and prevertebral lymph glands are swollen. The bone marrow is red.
When the phagocytic endothelial cells rupture the parasites are taken up by other cells and if by large mononuclear or polymorphonuclear cells may appear in the peripheral circulation. In possibly 80% of cases the parasites may be found after prolonged search in smears of peripheral blood. The leucopenia and large mononuclear increase are the blood features.
Symptomatology
Indian kala-azar.—As with all diseases tending to a chronic course it is difficult to be sure of the length of the period of incubation of kala-azar and various authorities have given it as from two to three weeks[129] to several months. Manson states that one of his cases developed the initial fever of the disease ten days after arriving in the endemic area. As a rule the period of onset is rather indefinite. There may be a history of daily rigors, so that malaria is suspected, but it is found that the fever does not respond to quinine. The fever is usually of a low remittent type, rarely a low continued fever, in which the temperature does not exceed 101°F. At times however in the early stage the remittent fever is of a high type, the temperature reaching 104°F.

Fig. 54.—Fever chart of a case of kala-azar reported by Bassett-Smith. This chart shows how easily one might confuse the temperature curve of this disease with that of Malta fever.
Rogers attaches particular importance to the fact that four-hour charts will show a double or even triple rise of fever in the twenty-four hours instead of the single one in typhoid fever. The patients also show a striking absence of typhoid malaise and apathy often stating that they feel well when the temperature may approximate 104°F.
The febrile accessions last from two to six weeks to be followed by periods of apyrexia and apparent improvement. Then follow further waves of fever and apyrexia so that the fever chart may resemble that of Malta fever.
In the early stages of the disease the loss of weight is apt to be marked. Later on, owing to improvement in appetite and increase in spleen, this is not so manifest.
The spleen begins to enlarge early in the disease and has usually reached the level of the umbilicus by the third month. In some cases there is little if any enlargement of the spleen even in the chronic stages. At times we note only an irregular fever with weakness, anaemia and emaciation. The liver does not usually become distinctly enlarged until about the sixth month.
The course of the disease in India is chronic often covering a period of one or two years. In the Sudan, however, Bousfield noted that the symptoms ran an[130] acute course, the average duration being only about 5 months. Rarely he encountered chronic cases with greatly enlarged spleen.
As the disease progresses anaemia and emaciation become marked so that the bulging spleen and liver in a dusky or earthy colored, skeleton-like native (black fever) make a striking picture. The lymphatic glands of cases in North China show enlargement.
Symptoms referable to intestinal ulcerations, such as diarrhoea or dysentery, are often noted at the end. Bleeding from the gums and nose is not infrequently noted.
The marked leucopenia, with accompanying decrease in the polymorphonuclears (the bacterial phagocytes), makes septic infections and pneumonia especially common in the course of kala-azar.
These complications frequently bring about a fatal termination so that we do not get the typical terminal cachexia with emaciation, exhaustion, dry brittle hair, petechiae, oedema and ascites. On the other hand the tendency of a bacterial infection to cause a leucocytosis may bring about a cure.
Infantile kala-azar.—The symptoms on the whole are similar to those of the adult type of kala-azar and differ only to the extent that might be expected in a disease occurring in very young children instead of in those older.
The onset is insidious with some fever and gastro-intestinal upset. The spleen enlarges, the child becomes apathetic, anaemic and emaciated. Irregular attacks of fever occur and the child often suffers from epistaxis, bleeding from the gums or haemorrhages into the skin. According to Nicolle a peculiar pallor of the skin is characteristic. Ulcerations of the intestines and noma may bring about a fatal termination. The liver does not enlarge to the extent that the spleen does. The finding of the parasites is necessary for the distinction of this infantile splenomegaly from those of other origin. The lymphatic glands are not usually enlarged.
Symptoms in Detail
Onset and Fever Chart.—The disease commences in a rather indefinite manner, often with gastro-intestinal symptoms or possibly daily rigors. The fever chart is that of a remittent fever with rather marked oscillations and in particular a double rise in the 24 hours, which Rogers regards as characteristic. The absence of a high continued fever and this double daily rise assist in differentiating typhoid. Waves of fever separated by apyrexial periods often simulate the fever chart of Malta fever.
The Spleen, Liver and Lymphatic Glands.—The splenic enlargement, which may reach the umbilicus by the third month, is the most characteristic clinical sign of kala-azar. The diagnosis was formerly made by spleen puncture but owing to many fatalities the liver puncture is to be preferred, although the results of such exploratory examinations are often negative, the liver being involved to a less extent than the spleen and rarely showing appreciable enlargement before the third month. It is during the pyrexial periods that the spleen and liver enlarge.
Cochran has brought forward the importance of examining smears from excised lymph glands for the parasites and others have shown that gland puncture is of value. The glands in the infantile type of the disease often do not show enlargement.
The Blood.—Marked anaemia is only found in the later stages and the color index is about normal. The number of red cells rarely falls below 2,000,000.
Leucopenia is characteristically marked, this having been below 2000 in 62% of Rogers’ cases. This authority considers the finding of 1 white to 1000 red cells, in a case of fever, very significant of kala-azar.
There is also an increase in the large mononuclear percentage which would aid in differentiating typhoid.
The coagulability of the blood is decreased and this may be a factor in the fatal results which at times follow spleen puncture.
Parasites are found in the peripheral circulation in about 80% of cases, after prolonged search, and may be phagocytized by either large mononuclears or polymorphonuclears.
Patton found parasites in the peripheral blood in the examination of a single slide in 42 out of 84 cases and with three slides in 25 of those not showing parasites with the first slide. By repeated examinations up to the seventeenth slide, he got positive results in all 84 cases.
The Sudan commission found that the alkalinity of the serum of their patients was diminished.
Rogers has noted an acidosis in unfavorable cases of kala-azar while those showing improvement only showed slight or no acidosis.
Respiratory and Circulatory Systems.—There is very little that is constant, the lungs being quite normal in 90% of Rogers’ cases. The pulse rate is rather variable, although usually accelerated.
Diagnosis
Clinical Diagnosis.—Cases of kala-azar are usually diagnosed as malaria and it is in the lack of response to quinine that we have our best point of differentiation.
In children showing splenomegaly the probability of the case being kala-azar rather than malaria is indicated if the case has shown progressive deterioration of health.
Malta fever shows a rather similar succession of febrile and afebrile periods but the spleen of the former rarely shows marked enlargement and the bronchial catarrh, sweatings, transient joint swellings and neuralgic manifestations are characteristic of Malta fever. Kala-azar may show muscular pains and slight sweatings and the differentiation has at times only been made by the laboratory diagnosis.
Typhoid and the paratyphoids are best differentiated clinically by the presence of a continued fever, the absence of a double daily rise and the existence of a more marked apathy.
The recent statements that hookworm disease may show enlargement of the spleen would make this a condition to differentiate. Hookworm ova and an eosinophilia indicate ancylostomiasis but there is always the question here as with malaria as to the existence of kala-azar and some other affection.
Laboratory Diagnosis.—The leukemias can be easily differentiated by the blood picture, an important matter because the spleen of spleno-myelogenous leukemia is very friable and the danger from splenic puncture is far greater in this condition than in kala-azar. Banti’s disease with its leucopenia shows a rather similar blood picture and can only be surely differentiated by the finding of leishman bodies in kala-azar.
While malaria may at times show a leucopenia below 4000, a polynuclear percentage below 50 and a large mononuclear one of 20 or more, yet the simultaneous appearance of all three is rare in malaria while common in kala-azar.
Malta fever, typhoid and the paratyphoids are best differentiated by blood cultures or agglutination tests.
Until recently it was recommended that for diagnosis our best procedure was to make a splenic puncture. Manson and others have pointed out the dangers from splenic puncture in kala-azar and have rather preferred puncture of the liver, although recognizing that the chances of obtaining parasites from a liver puncture, are less than from a splenic one.
Statistics have been given where a mortality approximating 1% has followed spleen puncture. Bousfield, however, using an all-glass syringe with a 1½ inch needle did not have a fatality in 120 spleen punctures.
For diagnosis the spleen or liver juice, rather than pure blood, is smeared on a slide and stained by some Romanowsky method, preferably that of Giemsa.
Cultures on N. N. N. medium can also be made.
Human blood seems to inhibit growth so that N. N. N. medium for cultivating Leishmania should be made from rabbit blood.
The culture should be kept at a temperature of about 22°C.
One should always first examine a smear of the peripheral blood for parasites in polymorphonuclear or large mononuclear leucocytes. The Sudan Commission found leishman bodies in the peripheral blood of 13 out of 15 cases so examined, but rarely did they find more than one parasite-containing leucocyte to a slide.
It is well to select a time when some pyogenic infection causes a leucocytosis.
Quite recently Wenyon and others have noted the desirability of culturing the peripheral blood in N. N. N. medium. Diagnosis may be made in this way, provided one wait from two to three weeks before reporting negatively as to the presence of flagellated Leishmania in the cultures. As before stated, strict asepsis and a room temperature are requisite for flagellate development.
It has been noted that artificial pustulation might assist in diagnosis by giving a multitude of polymorphonuclear leucocytes for examination for phagocytized Leishmania.
Cochran has recently noted the advisability of excising a lymphatic gland and making gland smears to examine for Leishmania. Others have reported success with gland puncture as utilized in the gland of trypanosomiasis.
Animal inoculation has no place in diagnosis as such a procedure is but rarely successful. Ray has recently proposed a turbidity test in which about 2 drops of blood are added to 20 drops of distilled water. Instead of giving a clear solution of haemoglobin we have a turbidity followed later by a white flocculent precipitate. It is now thought that this turbidity is due to excess of serum globulin in the blood of this disease and the test can be carried out with serum instead of whole blood.
Prognosis.—Kala-azar is a chronic disease in the great majority of cases although both the adult and infantile types may show cases rapidly running to a fatal termination. Marked intestinal disturbance makes for a bad prognosis as does also a low large mononuclear percentage. A marked leucopenia is a bad sign particularly when associated with such low polymorphonuclear percentages as ten to twenty. Rogers notes that in children the polymorphonuclears several times did not give more than 5% of the total leucocyte percentage.
The mortality is usually given as about 95% although Rogers states that he has reduced this to 75% by large doses of quinine. The action of antimony is that of a specific. Patients often succumb to complicating septic conditions or pneumonia.
Prophylaxis and Treatment
Prophylaxis.—The best results in India have been obtained by abandoning infected houses and establishing new ones for the non-infected villagers, which need not be more than 300 yards from the old ones, thus showing that mosquitoes and flies are probably not concerned in transmission. Measures directed against the bedbug seem to offer the best chance of success. Often, however, the bugs are so deeply located in cracks of thick-walled houses that they may not be reached by sulphur fumigation. Flaming of such crevices with a plumber’s lamp has been recommended.
Treatment.—Rogers has recommended quinine in doses of 60 to 70 grains daily, claiming thereby to have reduced the mortality of the disease to 75%.
Castellani recommends a combination of quinine and atoxyl, while Manson has reported success with atoxyl in 2 cases, giving 3 grains intramuscularly every other day.
Salvarsan has been tried, but without much success, as is also true of X-rays.
Some have tried cinnamate of soda with the idea of increasing the leucocytes.
With the purpose of increasing leucocytes Rogers has tried hypodermic injections of sodium nucleate and killed staphylococcus vaccines as well as splenic substance tablets. The sodium nucleate injections were most painful and did not increase the leucocytes. He had some success with tabloids of spleen substance.
If the blood serum shows a lessened alkalinity the intravenous injection of solutions of bicarbonate of soda should be tried.
Rogers reports very favorable results from the administration of alkalies by mouth.
Recently hectine has been recommended in infantile kala-azar.
Following the successful employment of intravenous injections of antimony tartrate in American leishmaniasis it has been used in Indian and infantile kala-azar.
Rogers has used the same treatment in Indian kala-azar with a considerable degree of success. He has also used a 5% ointment of finely divided antimony. The treatment should be continued until the temperature has been normal several weeks and the leucocyte count approach the normal.
Antimony may now be considered as a specific in the treatment of the leishmaniases.
Knowles, at Shillong, has had long experience and striking success with the intravenous administration of tartar emetic in kala-azar. The heavy powder alone should be used—not the light powder. A 1% solution is prepared in normal saline and the solution autoclaved for 10 minutes at 110°C. If there is any opalescence or deposit discard the solution. Knowles begins with the intravenous injection of 3 to 4 cc. for an adult and gives the injections on alternate days, increasing the dose until we are giving from 10 to 12 cc., the maximum dose. It will be noted that the dosage ranges from 3 to 10 centigrams (½ to 1½ grains). The amount of drug given for a complete course of treatment is 200 cg. (33 grains). In the latter part of the course of treatment the effects on the patient are more marked so that caution must be observed, and it may be necessary to lengthen the interval or reduce the dose. The injections should not be given within two hours of a meal. Organic disease of the heart or kidneys contraindicates the antimony treatment. Coughing, a metallic taste in the mouth and constriction of the chest are frequently noted following the injection. Nausea, colic and diarrhoea show that the limit of the drug has been reached and albuminuria and jaundice are signs of warning to decrease the dose or stop the treatment. Christopherson considers that 5 to 8 grains will cure oriental sore, but for kala-azar 60 grains may be necessary. This authority considers 3 grains of tartar emetic as the maximum dose intravenously. For children under 1 year of age the intravenous dose of the 1% solution is ¼ to 1 cc., from 1 to 5 years old 1 to 3 cc. and from 5 to 10 years of age 1 to 5 cc.
Manson-Bahr has reported the successful use of an organic preparation of antimony, the sodium salt of p-acetylaminophenylstibinic acid. It is a powder, readily soluble in water and has the trade name of “stibenyl.” It can be injected intravenously up to 0.8 gram. The drug contains 36% of antimony. Knowles advises the use of tonics and, when indicated, of anthelminthics. He also recommends cod liver oil to increase the weight.
Cutaneous Leishmaniasis
General Considerations.—There is good reason to believe that much that was written about oriental sore prior to our knowledge of its etiology referred to tuberculous, syphilitic and other ulcerative skin lesions. As regards the work done in the investigations as to etiology Cunningham, in 1885, described deeply staining bodies in cells which were larger than lymphocytes. Later, in 1901, Firth confirmed the findings of Cunningham, but considered the bodies as degenerative changes in the cells rather than entertaining the view of Cunningham that they were parasitic protozoa. The name Sporozoa furunculosa was given these parasites. As previously stated, Wright, in 1903, using his modification of the Romanowsky stain, found round or oval bodies, from 2 to 4µ in diameter, packed in the cytoplasm of endothelial cells, in smears from an oriental sore in a child from Armenia. He called the parasites Helcosoma tropicum.

As the result of our knowledge that such lesions are caused by leishman bodies, Leishmania tropica, we have been forced to include among such sores clinical types entirely different from the classical oriental sore of Fayrer or Tilbury Fox. Even a keloid type of lesion described by the workers in the Sudan is known now to be caused by leishman bodies. In 1909 leishman bodies were demonstrated in ulcerative processes from Brazil and since that time we have divided cutaneous leishmaniasis[136] into two groups, according to geographical distribution, that of the East, or oriental sore, and that of the West, or American leishmaniasis.
Oriental sore is found chiefly in North Africa, Asia Minor, Syria, Persia and India, and more recently cases have been reported from Italy and Greece and New Caledonia. American leishmaniasis is found chiefly in Central America, Brazil, Peru and the Guianas.
Epidemiology.—There is nothing definite known as to the epidemiology of cutaneous leishmaniasis. The fact that oriental sore almost always occurs on the uncovered parts of the body would suggest transmission by some insect as the house fly or mosquito rather than by the body louse, flea or bedbug, these latter showing no special preference for the uncovered skin.
There has been a great deal written about the origin of the disease in drinking water, various inorganic constituents having been incriminated as factors. In certain places, as Delhi, oriental sore has decreased among the British troops with the discontinuance of the use of water from certain city wells. We know that oriental sore is rather easily inoculable, it having been stated that certain people of Bagdad inoculated their children in order to insure against the possible appearance of the sore on the face with the resulting scar disfiguration. Wenyon found that the virus would not pass through the unabraded skin.
The disease is most prevalent about the end of summer and in the autumn. It is a disease of towns. Some have thought that it might be transmitted through the medium of the laundry. Not only can man be infected by inoculation but this is also possible with monkeys and dogs when a scarified area about nose or over eyebrows is inoculated with virus from a sore.
The lesions are similar to those in man but last a shorter time.
It has been suggested that the dog may be the reservoir of this virus as well as for that of infantile kala-azar. There is some experimental evidence to show that an animal which has recovered from a visceral leishmaniasis is immune to a cutaneous one.
There has been an idea that lizards or snakes might serve as the reservoir of virus for oriental sore and that species of Phlebotomus feeding on these reptiles might take in the flagellates and subsequently transmit them to man. Laveran, however, has been unable to infect lizards with L. tropica. Patton’s observations point to infection from the crushing of infected sandflies when biting the exposed surfaces of the skin.
The natural infection of man with oriental sore produces a rather lasting immunity.
As regards the American sores there is a great deal of difference of statement as to the probable transmitting agent. These sores seem to occur in forest regions where clearing of the trees is going on. Infections occur in late summer or autumn. Marshy districts appear to favour infection. Brumpt thinks the fact that dogs, which are susceptible as well as monkeys to inoculation with the American leishmaniasis,[137] are often bitten by ticks without the production of the sore, is against the view that ticks act as transmitting agents. He rather favors a tabanid fly and in a case reported by Darling the patient incriminated a tabanid fly.
Five cases are reported by Cerqueira as following the bite of Phlebotomus lutzi.
The disease seems to occur naturally in the dog in the infected regions.
Pathology.—In oriental sore there is an infiltration of the corium and its papillae with plasma and lymphoid cells as well as with large phagocytic cells packed with leishman bodies which cells Wright regards as endothelial cells. There is atrophy of the epidermis.
In the keloid type of leishmaniasis noted by the Sudan Commission epithelial cell nests were characteristic although there was no other evidence of epithelioma.
In the American leishmaniasis there is rather constant involvement of the lymphatic glands and often lymphangitis. Histologically the appearance is rather that of granulation tissue with occasionally giant cells.
Symptomatology
Oriental Sore.—Wenyon inoculated a scarified area on his arm which became infected with pyogenic organisms but eventually healed. It was thought that this inflammation would destroy any Leishmania which might have been present. About six months later he became ill and had fever up to 103°F. for a week with malaise and gastro-intestinal upset. At this time a small red papule was noted upon the site of the original scarification which subsequently enlarged and was found to contain leishman bodies.
The period of incubation is usually given as about two months, although in some instances it may be as short as a week. Usually the earliest appearance of the sore is similar to that of a mosquito bite. The papule continues to enlarge, becoming purplish in color with a glazed surface. It somewhat resembles an inflamed acne lesion. Growing larger, the surface of the blind boil-like lesions now becomes covered with brownish scales and, either from scratching of the rather pruriginous spot or from the development of vesicles, it becomes covered with a yellowish crust, beneath which is an ulcer with raised edges and discharging a thin offensive pus.
The ulceration does not generally occur before the third or fourth month. The ulcer is painless and may be an inch or more in diameter. Healing comes on in about seven to ten months, the yellowish unhealthy granulations giving place to healthy pink ones. The sore tends to run a course of about one year, hence the French designation bouton d’un an.
According to Weber’s statistics about 85% of the sores were located on the upper or lower extremities and about 10% on the face,[138] while the trunk served as the location for only about 5% of the sores. There are generally 2 or 3 sores.
According to Déperet and Boinet the number of sores to a case was one sore in 30%, 2 to 4 sores in 50% and from 4 to 20 in about 20% of cases.

American Leishmaniasis.—Under a number of names such as espundia, uta, bubas and forest yaws there has been found in many parts of Central and South America an ulcerating sore, more or less resembling oriental sore, but often associated with ulcerating granulomatous lesions of nasal and buccal mucosae. Da Silveira states that in Brazil about 20% of cases develop the mucous membrane lesions. He notes an incubation period of two to three months. In Venezuela the mucous membrane lesions are more rare.
The lymphatic glands and lymphatics are commonly affected.
Just as with oriental sore one or more pruriginous papular lesions appear on the uncovered parts of the body. In a few days it develops a pustular summit. This undergoes ulceration and after several months or even after the primary lesions have healed nodules may make their appearance in nose and mouth.
These ulcerate and form fungoid granulations. Even the larynx may be involved. The nasal septum and other cartilaginous portions of the nose are often destroyed and the overlying tissues become swollen and often eroded by ulceration, so that the[139] patients present the appearance of similar cases where syphilis, tuberculosis or leprosy may be the cause.
A point of distinction between syphilitic and leishmaniasis lesions of the nasal mucosa is that the latter do not involve the bony structures.
Rabello noted that a positive Wassermann may be present in cutaneous leishmaniasis which is in agreement with Sutherland’s findings of 27% positives in cases of kala-azar.
The patients suffer from fever, joint pains, bronchitis and general symptoms. After a long period of ten to twenty years, during which they often die of some intercurrent affection, there may be a terminal cachexia.

Diagnosis.—The diagnosis in either oriental sore or in American leishmaniasis can only be made surely by the finding of Leishmania,[140] either by scrapings from the edges of the ulcer or by culturing in N. N. N. medium the blood from the immediate site of the sore. Cultures were once obtained from the blood of a finger where the sore was located on the arm of the same side but usually the parasites are absent from the peripheral circulation. Gland puncture in American leishmaniasis may give positive findings of parasites.
Prophylaxis and Treatment.—Knowing that the application of material from a sore to a scarified surface will bring about infection, it would seem advisable to cover any abrasions or open wounds with flexible collodion or other protectives so as to prevent flies, which may have fed on oriental sores, from having access to the wound.
It has been recommended to paint the spot of insect bites with tincture of iodine.
Atoxyl and salvarsan have been tried in oriental sore and American leishmaniasis without any particularly striking curative results. Attempts have been made to excise the early lesions but unless one goes well beyond the infected area, severe recurrences may result. Bier’s passive congestion method has been tried without success.
An expectant treatment is usually resorted to, the crusts being softened and removed with antiseptic fomentations with subsequent disinfection of the ulcer with bichloride or potassium permanganate solution and the application of some antiseptic ointment or powder. Thorough cauterization with pure carbolic acid followed by rapid neutralization with alcohol can be tried. The injection of killed cultures of Leishmania does not seem to have been effective.
Wenyon has had good results from an ointment of equal parts of methylene blue, lanoline and vaseline in an American sore.
Carbon dioxide snow has been shown by Mitchell to be an efficient local application for oriental sore.
The remarkable effect of antimony on the parasites of leishmaniasis was first noted in the treatment of the cutaneous types. The treatment is similar to that described under kala-azar. The effect of the drug is less pronounced on the lesions of the mucous membranes.
CHAPTER IX
DYSENTERY
Definition and Synonyms
Definition.—The designation dysentery refers to a symptom-complex of (1) small, frequently passed mucous or muco-sanguinolent stools and (2) pains connected with spasm of the sphincter ani (tenesmus) or intestinal gripings (tormina).
The condition may be set up by numerous causes but of these two so outweigh the others that it is usual to have in mind either bacillary or amoebic dysentery when the term is employed.
Synonyms.—The Bloody Flux. French: Dysenterie. German: Ruhr.
General Considerations
As will be noted in the sections dealing with amoebic and bacillary dysentery our present knowledge of these conditions is of recent date. There was so much that was etiologically, epidemiologically and clinically contradictory that the subject was impossible of elucidation until the existence of a group of dysentery bacilli was generally accepted, following the reporting, in 1898, by Shiga, of his bacillus of dysentery.
Although Hippocrates was the first accurately to describe the disease we now know as dysentery yet there is good ground for believing that the disease existed in Egypt and India for centuries before Christ.
Many of the older writers failed to differentiate conditions which showed admixtures of mucus and blood in the stools from those with blood alone.
Commencing with the last century, authorities have considered the association of mucus with the blood as essential in clinical diagnosis.
It is interesting that with a better knowledge of etiology we are now recognizing as of dysenteric nature diarrhoeal conditions in which there is an absence of the typical stool of dysentery.
Our views as to the etiology and epidemiology of bacillary dysentery have been fairly definite for at least twenty years, while those relating to amoebic dysentery, notwithstanding the important researches of Kartulis, Councilman and Lafleur, Schaudinn and others have remained rather chaotic until quite recently.
The Term Dysentery.—By the term dysentery we understand a symptom-complex of more or less characteristic stools and more or less characteristic pains.
As a rule the stool is composed of one or more teaspoonfuls of greenish yellow or dirty brown mucus, the altered blood being intimately admixed with the mucus, or we may have a whitish to grayish muco-purulent mass with streaks or flecks of blood on the outside. These mucoid masses may be found suspended in serous, sanguineous or more or less feculent discharges which are usually small in amount and passed with much frequency.
The terms tormina and tenesmus are the ones used to designate the characteristics of the pains of dysentery, tormina for the griping colicky pains, which center about the umbilicus or run in the direction of the large intestine, and tenesmus for the painful spasmodic contractions of the sphincter ani to which is due the sensation of lack of ability to complete the act of defecation leading to straining and justifying Manson’s description “glued to the commode.”
It is usually stated that the nearer the dysenteric process is to the rectum, the greater the tenesmus and the nearer to the caecum, the greater the tormina.
The Modern Classification of Dysenteries is Based on Etiology Rather than upon Clinical Manifestations
Owing to the great importance of the two main kinds of dysentery, amoebic, or that caused by Entamoeba histolytica, and bacillary, or that caused by some strain of Bacillus dysenteriae, we shall consider them separately from the other causes of the dysenteric symptom-complex.
A. Dysenteries caused by animal parasites.
Protozoal dysenteries.
1. Amoebic dysentery (Entamoeba histolytica).
2. Flagellate dysenteries (Lamblia intestinalis, Trichomonas intestinalis and Chilomastix mesnili).
While in adults these intestinal flagellates usually cause only a diarrhoea, with at times marked nervousness, they may produce dysenteric symptoms in young children. The onset in children under three years of age may be insidious and attended with fever. The stool contains much mucus with only a little blood.
In cases of amoebic dysentery, the diarrhoeal attacks, which at times occur, are often associated with an abundance of flagellates, which may well be the cause of the complication. Cases of dysenteric diarrhoea have been reported from Gallipoli in which Lamblia (Giardia) were apparently the only parasites involved. Such stools are often of a yellow ochre color. Relapses are common features of Lamblia infections. Lamblia is an inhabitant of the upper intestine while[143] Trichomonas and Chilomastix belong to the large intestine, especially in the region of the caecum. While these last named flagellates are often found in the stools of those convalescent from dysentery there is a general opinion that they are nonpathogenic. These organisms may be present in diarrhoeal conditions in which case it is common to designate such diarrhoeas as flagellate diarrhoeas. Fantham and Porter have reported 187 cases of pure lambliasis.
In diagnosis it is important to recognize the encysted Lamblia. These are oval cysts, about 10 × 7µ and show a curved central line, with two lateral dots. When stained these dots show as chromatin areas. These cysts may be found in the faeces in great numbers. The vegetative Lamblia has 4 pairs of flagella, is about 15µ long and has a tumbling motion. Calomel alone or calomel and ipecac give good results at times. Enemata of organic silver salts may be of benefit.
Porter recommends bismuth salicylate. Low has noted the tendency of lambliasis to recur and thinks many of the reported cases of cures are only temporary. His experience with bismuth, salol, thymol and cyllin has not been encouraging.
It is well known that lambliasis is of rather frequent occurrence in mice and rats so that these rodents may be factors in spreading the infection through the agency of their faeces deposited about human food.
Of other drugs recommended in treatment Dobell and Low have had no success with methylene blue, turpentine or beta-naphthol. These authors failed to find any increase in either large mononuclears or eosinophiles in a case of the infection.
Since Lamblia inhabit the upper parts of the small intestine, it may be that the administration of drugs by the duodenal tube will prove an effective method of treatment. Owens reports successful results in the treatment of amoebic dysentery from ipecac so administered. Stiles has recommended sulphur in lambliasis.
3. Ciliate dysenteries (Balantidium coli).
While various ciliates may cause a severe type of dysentery it is very exceptional that others than Balantidium coli do so. This oval ciliate is from 60 to 100 microns long by about 50 to 70 microns broad. It is a commensal of hogs and the disease in man is usually found in those having the care of hogs. Infections have been reported from various parts of the world, temperate as well as tropical regions. These ciliates may be found in the faeces of persons apparently well but in such cases symptoms may eventually appear. The parasites multiply in the submucosa and the pathologic process is similar to that observed in the large intestine in amoebic dysentery.
The parasite is so large and has such an active motility that it would be impossible to fail to detect it in a microscopic examination of the faeces. Encysted parasites are round. The onset is rather insidious with diarrhoea which may be followed by dysentery. A severe form of anemia may be noted.
Ipecac, emetine, arsenic and quinine appear to be of little value in the treatment, but Walker considers the organic silver compounds, as protargol, etc., of value. Methylene blue enemata (1-3000) and 2-grain pills by mouth have been recommended.

Fig. 58.—Important pathogenic Protozoa of the intestinal tract. (1a) Motile E. coli. Note large amount of peripheral arrangement of chromatin in nucleus. (1b) Encysted E. coli. Note larger size than E. histolytica cyst, 8 ring form nuclei and absence of chromidial bodies. (2) Motile E. histolytica from acute dysenteric stool. Note histolytica nucleus with scanty chromatin. (3) Tetragena type of E. histolytica from case of chronic dysentery. Note greater amount of chromatin and central karyosome with centriole. (4a) Preëncysted E. histolytica from carrier. Note small size and heavy peripheral ring of chromatin in nucleus making this feature of chromatin in nucleus similar to the larger E. coli. (4b) Encysted E. histolytica from dysentery convalescent. Note small size, 4 ring nuclei and a dark chromatin staining mass, “chromidial body.” (5a and 5b) Motile and encysted cultural amoebae from Manila water supply. (6a and 6b) Oocyst and sporozoite production in 4 spores of Eimeria stiedae. (7a and 7b) Oocyst with 2 sporoblasts and oocyst with 2 spores containing 4 sporozoites of Isospora bigemina. (8a and 8b) Vegetative and encysted Trichomonas intestinalis. (9a and 9b) Vegetative and encysted Lamblia intestinalis. (10) Balantidium coli. Illustrations of amoebae from Walker—others from Doflein.
4. There are also dysenteric manifestations noted in the terminal stages of kala-azar (Leishmania donovani) and in algid pernicious malaria (Plasmodium falciparum). These conditions are taken up under the diseases kala-azar and malaria.
Wenyon noted a case of coccidial infection (Isospora hominis) in which there was a dysenteric syndrome. There have been about seventy cases of infection with this parasite reported, chiefly from soldiers serving in Gallipoli. The usual opinion is that they are nonpathogenic parasites. The oocysts are ovoid, with one end narrowed, and measure 28 × 14 microns. There are two sporocysts, each of which contains four sporozoites. The cyst when first passed is unsegmented.
Helminthic dysenteries.—1. In addition to the protozoal causes above noted we may have dysenteric symptoms following infections with trematodes, especially Schistosoma mansoni and S. japonicum. In these cases we have mucus coating the stool with more or less clotted blood in which mucus we may find the diagnostic ova. A rather high eosinophilia is present.
2. Infections with Gastrodiscus hominis also give rise to dysenteric manifestations.
3. A very small cestode, Heterophyes heterophyes, has been noted to cause a condition suggestive of dysentery.
4. In 1902, Brumpt noted the finding of a nematode, Oesophagostomum brumpti, in the large intestine of an African native, which caused dysenteric symptoms and, more recently, another species, O. stephanostomum, has been reported as causing a fatal dysentery in a Brazilian at Manaos.
5. There have also been reported cases with dysenteric manifestations which were apparently connected with intestinal myiasis.
B. Dysenteries caused by bacteria.
1. Those caused by either the more toxic, nonacid mannite strain of Shiga, or the less toxic, acid mannite strains of the Flexner group.
2. Morgan has reported as the cause of certain bacillary dysenteries a bacillus known as B. Morgan No. 1. It is motile, produces indol, and in glucose bouillon gives a very slight amount of gas. It does not change mannite and does not produce a primary acidity in litmus milk. This organism is a frequent cause of summer diarrhoea of children. Flies from houses with such cases often show Morgan’s bacillus.
Paratyphoid infections may give the clinical picture of a colitis and such cases at times show a large amount of blood in the dysenteric stools. Usually the symptoms are rather those of an entero-colitis or a gastro-enteritis.
3. In Japan, dysentery-like epidemics of a very fatal disease, termed ekiri, occur among young children. The organism is very motile, producing gas and acid in glucose, but not in lactose media. It is reported at times to show indol production. Apparently a member of the Gärtner group.
4. Spirillar dysentery. LeDantec has reported a type of dysentery which shows the presence of great numbers of spiral forms. These are Gram negative and noncultivable. It is in question whether they belong to the bacteria. There is no fever in this type of dysentery.
5. Other bacterial causes. Cases of dysentery have been reported as caused by B. pyocyaneus, streptococci, atypical B. coli and organisms of the Gärtner group.
In a Pyocyaneus infection the color of the stools would be suggestive. This cause should be borne in mind in the dysenteric infections of debilitated children in the tropics. Some of the cases of so-called ptomaine poisoning due to members of the Gärtner group have clinical similarities to dysentery especially at the commencement of the attack.
C. Dysenteries resulting from mechanical irritants or poisonous substances.
A very interesting form of poisoning which gives rise to serious illness or death and is attended with marked abdominal pain and manifestations of dysentery is that reported from North China through the use of short lengths of bristles which are given mixed with the food.
Various irritant metallic poisons as arsenic, antimony and mercury may give rise to dysenteric symptoms. In cancer and syphilis of the rectum there may be a suspicion that the process is an ordinary dysenteric one.
Intussusception shows marked tenesmus with bloody rather than muco-sanguineous stools.
While dysenteric symptoms may be present in the terminal stages of various chronic diseases, especially tuberculosis and cardiac affections, yet it is in chronic nephritis, leading to uremia, that we may see symptoms of a marked catarrhal or even diphtheritic colitis.
CHAPTER X
AMOEBIC DYSENTERY
History and Geographical Distribution
History.—Lambl, in 1859, was the first one to note the presence of amoebae in man, these being found in the stools of a child affected with diarrhoea. It was Lösch, however, who, in 1875, first accurately described the parasite which he found in the intestinal ulcerations as well as in the stool of a patient with chronic dysentery and was able to produce dysenteric ulcerations in the dog, by injecting amoebae-containing faeces into the dog’s rectum.
In 1879 Grassi noted the encysted forms of amoebae, but as he found them in well people, he denied their pathogenic importance. Cunningham found amoebae in the stools of cholera patients and Perroncito in those of typhoid cases, both of these authorities, however, viewing the question of their pathogenicity as did Grassi.
This was the general attitude of the medical mind until Koch, in 1883, while investigating cholera in Egypt, was impressed with the striking penetration of amoebae in the walls of intestinal ulcers and considered that this fact favored the view that amoebae were pathogenic.
Kartulis continued the work of Koch and in 1886 published his findings in 150 cases of dysentery, noting the presence of amoebae in the stools of all these cases. In 1887 he noted the presence of amoebae in liver abscess. In 1891, Lutz noted that amoebae in dysentery contained red cells. In the same year Councilman and Lafleur came to the conclusion that there were two species of amoebae in man, one harmless and the other, which was found in the submucosa of intestinal ulcers, pathogenic, Casagrandi and others put forward the view that amoebae only acted as carriers for bacteria, but in 1893 Kruse and Pasquale injected all the bacterial species isolated from a dysenteric stool into a cat’s rectum with negative result. Hlava and Kartulis first produced dysenteric lesions in cats by injecting per rectum, amoebic stools. Kruse and Pasquale produced dysentery in cats by injecting per rectum bacteria-free pus from a liver abscess which however contained amoebae.
A stumbling block as to the connection between amoebae and dysentery was the fact that many cases of typical dysentery failed to show amoebae. In 1898 Shiga settled this matter by reporting a group of bacilli which were concerned in the production of dysentery. His findings were confirmed all over the world and the distinction gradually obtained of cases of dysentery from bacillary as well as from amoebic infections.
In 1903 Schaudinn reported the existence of two species of amoebae, one harmless and named Entamoeba coli, the other pathogenic and named E. histolytica. In 1907 Viereck described a pathogenic amoeba which, by reason of its four nuclei in the encysted stage, he called E. tetragena.
As the result of the work of Hartmann, Whitmore, Darling, Wenyon and the recent conclusive findings of Walker we now hold the view that Schaudinn was working with E. tetragena and not with a separate species, so that by the law of priority we must drop the name E. tetragena and accept E. histolytica.
Geographical Distribution.—Amoebic dysentery seems to be especially prevalent in Indo-China, China and the Philippines, as well as in parts of India. It is also very common in Egypt and Northern Africa. In South America, especially Brazil, it is common, as is also true of the West Indies and Central America. It is an important disease in the Southern States of the United States, as well as in Italy and other parts of Southern Europe. On the whole it is probable that it exists in greater or less degree in most of the tropical and subtropical parts of the world.
Etiology and Epidemiology
Etiology.—For a long time the authorities in Manila held that it was impracticable to differentiate between a pathogenic and nonpathogenic species, taking the view that the principal factor in the production of dysentery was that of symbiosis between amoebae and suitable bacteria, it having been thought that they observed in cultures of amoebae evidences of both symbiosis and antagonism on the part of amoebae to certain species of bacteria. They furthermore were convinced that pathogenic amoebae could be cultured on a medium of about 1/10th the strength of ordinary nutrient bouillon or agar and that dysentery could be produced by such cultural amoebae. Such views had an important bearing on epidemiology as it was thought that where amoebae could be cultured from green vegetables, fruit, or water supply there was positive evidence of the possibility of infection with amoebic dysentery from such a source.
The above views are no longer entertained and, due to Walker, working in Manila with experiments on man, we now know that cultural amoebae are without effect in the production of dysentery and that there are certainly two well known species of amoebae having man for a host, the one pathogenic, Entamoeba histolytica, and the other a harmless commensal, Entamoeba coli. Two other species, Endolimax nana and Iodamoeba bütschlii, have recently been described but are generally considered nonpathogenic.
Some authorities prefer the generic names Löschia and Endamoeba to Entamoeba.
Schaudinn, in 1903, described the pathogenic amoeba, which he named E. histolytica, as follows: 1. Distinct, highly refractile and tenacious ectoplasm. He considered this tough external portion of the cytoplasm as the explanation of the ability of the pathogenic amoeba to bore its way into the intestinal submucosa. 2. Eccentric nucleus which was indistinct by reason of little chromatin. 3. Reproduction by peripheral budding in which small aggregations of chromatin reached the periphery of the cytoplasm and, enclosed in a resistant capsule, broke off from the parent amoeba and constituted the infecting stage.

For the nonpathogenic E. coli he noted: (1) No distinction between a granular endoplasm and refractile ectoplasm; (2) centrally placed and sharply outlined nucleus, rich in chromatin; and (3) encystment with the formation of eight nuclei, which cysts with their nuclei or amoebulae form the infecting stage.
The pseudopodia of E. histolytica are actively projected as long finger-like processes which show the ectoplasm quite distinctly, while the pseudopodia of E. coli are lobose and sluggishly projected and show a uniformly opaque grayish color. In dysenteric stools E. histolytica tends to show contained red cells. E. coli never contains them but instead shows bacteria and food particles.
In 1907 Viereck and later Hartmann recognized a pathogenic amoeba with four nuclei in its encysted form, to which was given the name E. tetragena.
All authorities now consider that Schaudinn made an error in observation as to the existence of peripheral budding for E. histolytica, so that we recognize but two types of encystment, one with a larger cyst and thicker cyst wall, with eight nuclei and an absence of chromidial bodies—E. coli—the other, smaller, with a thin cyst wall one to four nuclei and chromidial bodies in the encysted stage, the pathogenic amoeba, E. histolytica. Synonym, E. tetragena.
In the vegetative stage the human amoebae are best differentiated by the nuclear structure as shown in stained specimens. In E. coli the nucleus is vesicular with a thick nuclear membrane and the chromatin chiefly deposited on the under surface of the nuclear membrane. This chromatin often seems deposited in quadrant aggregations. The karyosome is eccentric.
For the pathogenic amoeba we recognize a histolytica type of nucleus, which is found in dysenteric stools, and a tetragena type, which is found in diarrhoeal or more or less normal stools. Dobell does not recognize this differentiation.

Fig. 60.—The more important intestinal amoebae of man showing nuclear structure when stained. 1. E. histolytica. 1(a). E. histolytica cyst. 2. E coli. 2(a). E. coli cyst. 3. E. nana. 3(a). E. nana cyst. 4. I. bütschlii. 4(a). I. bütschlii cyst. (After Dobell.)
The histolytica nucleus has a thin nuclear membrane and is poor in chromatin while the tetragena nucleus has more chromatin, showing radial projections from the inner surface of the nuclear membrane, and a loose central spherical karyosome, which contains a central chromatin dot or centriole, with a clear halo surrounding it. Dobell states he has not been able to note this centriole.
The preëncysted E. histolytica has a nucleus resembling that of E. coli. The smaller size and chromidial bodies are differentiating.
Animal experimentation upon kittens with E. coli by Schaudinn, Craig and Wenyon have been unsuccessful as to production of dysenteric manifestations. On the other hand all of these experimenters produced typical lesions and dysenteric manifestations in kittens injected rectally or fed with material containing pathogenic amoebae.
Wenyon as previously stated produced a liver abscess in one of his experiments.
Darling has been so successful in his experimental work with kittens that he compares the colon of a kitten to a test tube and suggests the procedure of rectal injections of material containing amoebae as a means of differentiating the two human amoebae.
On the other hand Walker was unable to infect kittens and monkeys with material containing pathogenic amoebae and he makes the statement that such failures would indicate the greater susceptibility of man to infection, as he was able to infect 17 out of 20 men with one feeding of such material.
Sellards and Baetjer note that inoculation of kittens per rectum or by feeding dysenteric stools rich in amoebae has resulted in infection in about 50% of experiments.
By inoculating the material directly into the caecum they were able to infect every one of their kittens. They were also able to propagate a strain of amoebae through a series of animals for several months.
The intracaecal inoculations yielded positive results in diagnosis of human amoebiasis when the clinical manifestations were obscure and the amoebae in the discharges so few and atypical as to make such an examination unsatisfactory.
Other Intestinal Amoebae.—It is a remarkable fact that one of the most common of the intestinal amoebae, Endolimax nana, has only recently been reported (Wenyon and O’Conner in 1917). In the examination of the stools of American soldiers Kofoid found it present in 28% of his examinations while E. coli was present in 23% of cases and E. histolytica in 9.3%. In examining 156 British soldiers Dobell noted its presence in 33% of them. The general view is that it is not pathogenic but its great importance is in the possibility of its being mistaken in its cyst form for E. histolytica. The living amoeba averages about 8 microns but in stained specimens it is somewhat smaller. In freshly passed faeces the amoeboid motion is sluggish and the nucleus indistinct. This amoeba is best identified by haematoxylin stained specimens when the nucleus shows a measurement of about 2 microns with a large eccentric karyosome which exhibits a variety of form. Unless perfectly fresh material is stained the degenerative changes in the amoebae may give a signet ring appearance of karyosome and ring nucleus. Such an appearance may suggest the limax nucleus. The mature cysts are usually oval, but sometimes round, and contain 4 nuclei, but when newly formed may only have one nucleus. The nucleus is large in the uninucleate form (up to 3 microns) but in the quadrinucleate forms it is about 1.2 microns with a large eccentric mass of chromatin. Chromidial bodies are rarely, if ever, present in these cysts.
Iodine Cysts.—These bodies which stain a deep brown colour when treated with iodine are now recognized as amoebae and have been named Iodamoeba bütschlii. They are most probably nonpathogenic. It is a small amoeba (9 to 13 microns, rarely up to 20 microns) and shows the sluggish movements of E. coli. The nucleus is very difficult to discern, thus differing from E. coli. In stained specimens it has a[152] vesicular nucleus about 2 microns in diameter with a fairly large central karyosome. The cysts are spherical or oval, often of irregular outline and are about 10 microns in diameter. The nucleus is large and eccentrically placed and has a karyosome which tends to show as a peripherally placed mass. There is almost always present a large glycogen mass in the cyst which stains intensely with iodine.
Dientamoeba Fragilis (Jepps and Dobell 1918).—A rare binucleate amoeba averaging 8-9 microns in size. Nuclei show a fairly large, central granular karyosome and no peripheral chromatin. Strands of linin may be seen radiating from karyosome to nuclear wall. This organism is said to be frequently mistaken for Blastocystis when the vacuoles coalesce leaving a thin ring of cytoplasm. Cysts unknown. Considered nonpathogenic. Recently Kofoid and Swezy reported another species of amoeba parasitic in man, Councilmania lafleuri. The adult and cystic stages resemble in many respects the E. coli. Adult said to ingest red blood cells. Stated to be pathogenic but that more evidence is needed on this point.
Human Experiments.—Recently Walker and Sellards have published a most important paper.
The experiments were made in men who had been under observation for years at Bilibid Prison, whose food was cooked and the water they drank distilled. Moreover, there were complete records of examination for intestinal parasites, including entamoebae. They were under complete control and the existence or possibility of natural infection with amoebae was reduced to a minimum. All the men fed pathogenic amoebae were volunteers and each signed, in his native dialect, an agreement to the conditions of the experiment.
The first series of experiments was with cultural amoebae, in order to refute statements that amoebae cultivated from water or other nonparasitic sources, as well as from dysenteric stools, are capable of living in man parasitically or of producing dysenteric symptoms. Twenty feeding experiments on ten men were made by Walker and Sellards with cultures of amoebae without the development in a single instance of dysentery or the finding of such amoebae in the stools upon microscopical examination. In 13 cases they recovered the amoebae in cultures from the faeces from the first to the sixth day, but never afterwards. They stated definitely that cultural amoebae are nonpathogenic.
The next experiments were with Entamoeba coli. In the 20 cases fed with material containing Entamoeba coli there was a uniform failure to recover them culturally and in no instance was dysentery produced. Seventeen became parasitized as the result of a single feeding in from one to eleven days, the entamoebae being found in the stools and persisting in their appearance in the stools for extended periods. They concluded that Entamoeba coli is an obligate parasite, nonpathogenic, and cannot be cultured.
The third series of 20 feedings, carried on by Walker alone, was with Entamoeba histolytica. The material was mixed with powdered starch or magnesium oxide and given in gelatin capsules. In these experiments they obtained tetragena[153] cysts in the stools of men fed only motile Entamoeba histolytica, and motile Entamoeba histolytica in the stools of men who were fed only tetragena cysts and, finally, an alternation of motile E. histolytica and tetragena cysts in the stools of a man having a recurrent attack of amoebic dysentery.
Results.—Seventeen of the men became parasitized after the first feeding; 1 required three feedings, and 2, who did not become parasitized at the first feeding, were held as controls. The average time for parasitization was nine days. Only 4 of the 18 parasitized men developed dysentery, which came on after twenty, fifty-seven, eighty-seven, and ninety-five days, respectively, after the ingestion of the infecting material.
In 4 cases fed with material from acute dysenteric stools or from amoebae-containing pus from liver abscess, and containing motile amoebae, there was no resulting dysentery, the 4 cases of experimental dysentery resulting from feeding of material from normal stools of carriers.
As regards the cases which became parasitized, but did not develop dysentery, it is suggested that the amoebae live as commensals in the intestine of the host and only penetrate the intestinal mucosa and become tissue parasites when there occurs depression of the natural resistance of the host or as the result of some lesion of the intestine. That the pathogenic amoebae are more than harmless commensals, however, is shown by the fact that they alone, and not the nonpathogenic Entamoeba coli, are capable of penetrating a possibly damaged intestinal mucosa.
Epidemiology.—The chief factor in the spread of amoebic dysentery would seem to be the encysted amoebae in the stools of convalescents, or symptomless carriers, rather than the motile amoebae in dysenteric stools. When such carrier has to do with the preparation of food, he becomes a particular source of danger.
This probably explains the endemic rather than the epidemic characteristics of the spread of amoebic dysentery because, if the innumerable vegetative amoebae in dysenteric stools were equally operative with the more sparsely eliminated cysts, there would be epidemics of amoebic dysentery similar to those of bacillary dysentery. The old idea that water, fruit or vegetables, from which one can isolate amoebae on culture, are sources of infection must be abandoned, as such cultural amoebae are known to have no pathogenic relation to man.
Vegetative amoebae undergo disintegration in a short time after the stool is passed, so that they are probably rarely concerned in amoebic infections but the resisting cysts may be washed from a dried stool into a water supply or even be transported in dust to lodge on unprotected foodstuffs.
Flies may possibly act as transmitting agents. As bearing on the probable importance of such flies as Musca domestica and Fannia canalicularis in transmitting amoebic infections may be noted the findings of Wenyon that the faeces of such flies, as well as Lucilia and Calliphora, after feeding on cyst-containing human faeces, teem with such cysts. In a dissection of 1027 house flies caught in Mesopotamia Buxton found ova of parasites of man in 4.09%. The percentage of infection with E. histolytica cysts was O.3%.
Pathology
Wenyon thinks that the pathogenic amoebae work their way into the tubular glands of the intestines and multiply and subsequently, either by pressure of their pseudopodia or through the disintegrating action of some toxic substance elaborated by them, they force their way into the underlying submucosa. In this location they produce a gelatinous, oedematous necrosis, which shows a marked absence of polymorphonuclears, but a proliferation of connective tissue cells. The process is regenerative rather than inflammatory.
Small hemispherical elevations of the overlying mucosa mark the location of the deeper-lying necrotic process. With the multiplication of the amoebae and the extension of the necrotic process in the submucosa we have thrombi formed in the terminals of the portal vein and possibly in those of the mesenteric arteries, which in the former case may result in emboli being swept up the portal vein to lodge in the liver and form a starting point for a similar necrosing process there or, as the result of interference with the blood supply of the overlying mucosa, cause this to undergo necrosis and be cast off as a slough, leaving an oval or irregular ulcer with deeply undermined edges and a floor formed by the muscular coat. The ulcers may be no larger than a pin’s head or they may be 1 or 2 inches in diameter or by coalescence be still larger. The gelatinous necrosis in the submucosa always extends beyond the limits of the necrosis of the mucosa, thus explaining the undermining. At times the muscular coats of the intestines are involved thus leading to a slough which involves all coats except the serous one. Bacterial infection, with coagulation necrosis of the mucosa overlying the amoebic process, is also responsible for some of the tissue destruction.
The amoebic ulcerations rarely extend above the ileo-caecal valve but may involve the entire large intestine. Rogers and Lafleur found the lesions most often in the caecum and ascending colon, often limited to this area.
The appendix was involved in 7% of the Manila autopsies. Often mild cases may only show lesions in the caecum. When there is a tendency to perforation the omentum will often be drawn over to the location of the threatened perforation. There is often thickening of the intestine in one place with cicatricial contraction of the lumen and thinning in another, so that there is an appearance of great irregularity.
Symptomatology
The great majority of cases of amoebic dysentery run a chronic course with periods of improvement alternating with recurrences of pains and dysenteric stools. From Walker’s experiments the period of incubation would appear to be from one to three months. The onset[155] in such cases is very insidious and the patient may complain more of diarrhoeal than dysenteric manifestations. Such patients often give a history of passing three or four pultaceous stools daily and complain of tenderness in the region of the caecum or along the course of the large intestine. One may determine some thickening of the colon in a thin subject.
Fever is absent and there are very few of the toxic manifestations which often accompany bacillary dysentery, such as headache, nausea and a mildly delirious state. There is progressive loss of weight and strength with the development of neurasthenic symptoms. The skin becomes dry and earthy and we have the picture of a more or less marked secondary anaemia. It is in these cases that we should be on the lookout for grayish green or grayish brown mucoid masses which can usually be found during an exacerbation. Sloughs of the gelatinous-like necrosis in the submucosa usually contain amoebae.
The X-ray has been utilized to give location of amoebic ulcerations. Bismuth is used for several days prior to taking the photograph and fills the sites of ulceration.
Such cases usually show a moderate leucocytosis in which the percentage of large mononuclears is increased and a very important point is that with tenderness about the caecum, plus a leucocytosis, one may diagnose appendicitis and operate on a normal appendix. Autopsy records however have shown that the appendix is not infrequently invaded by amoebae but in some of these cases, other than finding amoebae in the lumen of the appendix, I have been unable to note any change. Cases of amoebiasis confined to caecum and ascending colon may only show symptoms of slight anaemia.
Besides the more common insidious chronic type we may have amoebic dysentery setting in quite acutely with severe griping and frequent scanty grayish green to reddish brown mucoid stools.
Such cases may show anorexia and nausea with some fever but there is not present the manifestations of toxemia one associates with a severe case of bacillary dysentery in the tropics.
Very confusing cases are those in which a bacillary dysentery sets in upon an amoebic one and this possibility should always be thought of when a severe bacillary dysentery does not respond to serum therapy or an amoebic one to emetine.
Gangrenous lesions may occur in amoebic dysentery although more common in bacillary infections. Such cases will show extreme prostration and even give the clinical picture of cholera.
Complications.—By far the most important and serious complication of amoebic dysentery is liver abscess, which occurs in about 20% of cases. This condition is treated of separately. Besides liver[156] abscess quite a number of cases of amoebic abscess of the brain have been reported, 26 such cases occurring in Egypt alone. These abscesses almost always occur in those cases which have developed liver abscess and may appear after the liver abscess has healed.
The pus of such abscesses is viscid and blood-tinged, resembling liver abscess pus. The amoebae are found in the abscess wall. The symptoms are those of brain tumor, meningitis not occurring. Necrotic processes of skin and muscles have also been reported in which amoebae have been found.
Perforation of the large intestine is not rare, Strong having noted 12 perforations in 77 autopsies. These usually occur in the region of the sigmoid flexure.
Adhesions are common complications of amoebic dysentery.
Diagnosis
Clinical Diagnosis.—In the clinical diagnosis it is well to remember that many cases of chronic tropical diarrhoeas are really due to amoebic ulcerations of the intestines.
We can as a rule differentiate bacillary from amoebic dysentery by the more sudden and acute onset of the former together with fever and other evidences of toxaemia. The pulse rate is more rapid in bacillary than amoebic dysentery. Again the number of stools in bacillary dysentery is usually greater and the amount of each stool less in quantity. The stool of bacillary dysentery is of a milky whiteness from the large number of pus cells or composed of gelatinous, reddish mucus, while that of amoebic dysentery is tinged with disintegrated blood giving it a grayish-green or brown color. The mucopurulent mass in bacillary dysentery may be flecked or streaked with blood. The therapeutic results following emetine injections are of value in diagnosis.
Gangrenous types of dysentery are similar whether due to bacillary or amoebic infection. Chronic dysentery of bacillary origin is much like amoebic dysentery clinically.
Manson-Bahr and Gregg recommend the use of the sigmoidoscope in the diagnosis of chronic amoebic ulcerations. In the evening the patient takes ½ ounce of castor oil and the next morning a soap and water enema is given followed by 15 minims of laudanum. The patient is put in the lithotomy position. No anaesthetic is used. The pain in introducing the instrument is greater in chronic bacillary ulceration cases than in amoebic ones. Scrapings can be made for microscopic examinations. Nisbet has reported the diagnosis of a case of balantidial ulceration by use of the sigmoidoscope.
Laboratory Diagnosis.—The mucoid mass of amoebic dysentery is often brownish. The pathogenic amoeba shows active finger-like processes and in acute attacks often shows contained red cells. In the fresh specimen of the milky mucopurulent mass of bacillary dysentery one observes large numbers of pus cells and particularly very large[157] phagocytic cells which greatly resemble amoebae. Upon staining with Gram’s stain one may find numerous Gram-negative bacilli in the cytoplasm of this cell.
These large cells which resemble amoebae are often vacuolated, thus intensifying the similarity. They are nonmotile, however, and do not show the small ring nucleus which is so characteristic of the vegetative human amoebae. The nucleus of the confusing cells is also larger, approximating one-fourth the size of the cell.
Bacillary dysentery stools show an absence of Charcot-Leyden crystals which are often present with amoebic stools.
For bringing out the nuclear characteristics of human amoebae Walker recommends fixation of thin moist smears in Giemsa’s sublimate alcohol (absolute alcohol 1 part, sat. aq. sol. bichloride 2 parts) for 10 to 15 minutes. These smears are then well washed with water and stained with alum haematoxylin for five minutes. The nuclear characteristics are noted under etiology. In such staining the preparations, which are best made on cover-slips, should never be allowed to become dry.
An excellent iron haematoxylin method is that of Rosenbusch:
Rapidly smear out with a toothpick a small particle of faeces or other material containing protozoa and, while still moist, fix by Giemsa’s method and, after getting rid of the mercury with iodine solution followed by 95% alcohol, treat smears with a 3.5% solution of iron-alum in distilled water for one-half hour or overnight, then wash thoroughly in distilled water.
Then stain from five to twenty minutes in the following haematoxylin stain: (1) 1% solution of haematoxylin in 95% alcohol. It takes at least ten days to ripen. (2) A saturated solution of lithium carbonate. Add to 10 cc. of the haematoxylin solution 5 to 6 drops of the lithium carbonate one. Next wash well and differentiate with about 1% solution of the iron-alum. Again wash in water, pass through alcohols to xylol and mount in balsam. With vegetative amoebae I have obtained beautiful results with vital staining which can best be done by tinging the faeces emulsion with a 1% aqueous solution of neutral red. I have also had good results by emulsifying the faeces in a drop of 1 or 2% formalin and then adding a drop of 2% acetic acid. The mixture is then tinged with either neutral red or methyl green.
For distinguishing the encysted form of Entamoeba coli one can obtain excellent results by emulsifying the faeces in Gram’s iodine solution. Owing to the glycogenic reaction given by E. coli, the round amoeba, with its 8 nuclei stands out very distinctly.
For diagnosing the 4-nucleated cyst of the pathogenic amoeba one gets better results with haematoxylin as this brings out not only the 4 nuclei but the chromidial bodies as well. It was formerly customary to recommend the administration of salts prior to examining for amoebae. Walker warns that such a procedure gives us amoebae which are difficult to differentiate, the nuclear characteristics of E. coli and the tetragena nucleus of E. histolytica being much alike as they both contain much chromatin. In a dysenteric stool the histolytica type of nucleus, containing but little chromatin, does not resemble the nucleus of E. coli.
He prefers the examination of formed stools obtained without a purgative.
Differentiating Characteristics of Pathogenic Amoebae (After Dobell and O’connor).
Motile Stage
| Entamoeba histolytica | Entamoeba coli | Endolimax nana | Iodamoeba bütschlii | |
| Size | 20-30µ | 20-30µ | 6-12µ | 9-13µ |
| Motility | Very characteristic. Flows in almost straight line across field. Later becomes less active pushing out a few, large blunt, blade-like pseudopodia which are perfectly hyaline being composed entirely of ectoplasm. | Usually sluggish but may show considerable activity when freshly passed. The movement consists chiefly in changes of shape without progression. | Slow progressive movement when freshly passed. Later slight changes of shape. Soon rounds and dies. | Slight motility with movements similar to E. coli. Quickly degenerates and dies. |
| Cytoplasm | Endoplasm finely granular and uniform in appearance. May contain red blood cells but bacteria probably never seen in normal individuals. Ectoplasm clear and well developed. | Endoplasm had a bulky granular appearance and contains numerous food vacuoles charged with bacteria and vegetable débris. Never contains red blood cells. No sharp line between endoplasm and ectoplasm. | Endoplasm finely granular with numerous minute food vacuoles containing bacteria. No sharp line as a rule between the endoplasm and ectoplasm. | Endoplasm finely granular and homogeneous. Usually contains numerous food vacuoles charged with minute bacteria. Cysts of this amoeba have previously been described been described as “iodine cysts.” |
| Nucleus | 4-7µ. A delicate vesicle inconspicuous or invisible. Stained shows fine beads of chromatin lining wall. Karyosome small, spherical and central. | 4-7µ. Distinguishable. Stained shows larger beads of chromatin lining wall. Karyosome spherical, eccentric and larger than that of E. histolytica. | 1-3µ. Vesicular with delicate membrane. Stained shows wall free from chromatin. All chromatin contained in large, irregular, eccentric karyosome. Variations in shape of karyosome characteristic. | 2-3.5µ. Small vesicle with distinct membrane. Stained shows wall free from chromatin as a rule. Typically chromatin contained in large, central spherical karyosome. Zone between nuclear wall and karyosome filled with single layer of small granules. |
Encysted Stage
| Entamoeba histolytica | Entamoeba coli | Endolimax nana | Iodamoeba bütschlii | |
| Size | 7-15µ | 15-20µ | 7-9µ | 9-12µ |
| Shape | Round. | Round. | Usually oval. | More or less rounded. |
| Wall | Thin. | Thicker than E. histolytica. | Thin. | Relatively thick. |
| Nuclei | Typically shows four nuclei. May show one to four. Nuclei at rest structurally similar to that of adult nucleus. | Typically shows eight nuclei. May show one to twenty. Structurally similar to adult nucleus. | Very small. May show from one to four nuclei. Rarely eight. Structurally similar to adult type of nucleus. | One relatively larger nucleus. Differs structurally from the adult type in that the granules in the clear zone become massed at one pole giving an eccentric karyosome. |
| Chromatoids | Large chromatoids common. | Large chromatoids may be present but usually absent. | Absent. | Absent. |
| Glycogen | Diffuse but not abundant. | Relatively abundant in the early stages. Scanty or absent in mature cysts. | Rarely present. | Dense glycogen mass is characteristic. |
Walker also notes the advantages of examining a specimen with a ⅔ inch objective as encysted amoebae are easily picked up. In opposition to the usual recommendation of text-books to report only on motile amoebae, he recommends the making of a differential diagnosis on nonmotile encysted forms. This however is now generally accepted by experienced workers as true.
The preëncysted E. histolytica has a nucleus much resembling that of E. coli. The presence of the same chromidial bodies one notes in the cysts is an aid in recognizing this stage. The 4 nuclei of the cysts are much smaller than the nucleus of the preëncysted or vegetative stage.
Prophylaxis and Treatment
Prophylaxis.—The main consideration is a knowledge of the importance of the carrier problem. The stools of all persons preparing food in localities where amoebic dysentery is prevalent should therefore be examined for the 4-nucleated cyst of the pathogenic amoeba. It must be remembered that while emetine controls the dysenteric manifestations of amoebiasis it does not seem to cause the disappearance of the parasite, so that patients who have had amoebic dysentery tend to become carriers.
As a matter of fact there is a question as to the possibility of the emetine treatment acting as a factor for the increase of carriers.
Vedder considers that while emetine will kill the amoebae deeply placed in the submucosa it has no effect on the more superficially located cysts and suggests that it may be possible to treat carriers by colonic irrigations with quinine or silver salts.
Emetine bismuth iodide has recently been highly recommended as our best agent for eradication of E. histolytica cysts of carriers.
Treatment.—The emetine treatment may now be considered as the specific one for amoebic dysentery. In Brazilian ipecac about 72% of the total alkaloids is emetine, so that it is better than Carthagena ipecac which contains only about 40% of emetine. Emetine was recommended for dysentery as long ago as 1817, but owing to the impossibility of differentiating between bacillary and amoebic dysentery, until recently, this method of treatment was little advocated.
In 1910 Vedder found that emetine was practically without power in its action on dysentery bacilli but that it would kill amoebae, even in dilutions of 1 to 100,000. He also found that deëmetized ipecac was quite inert in its action on amoebae.
In 1912, Rogers, who had for years been an ardent advocate of the ipecac treatment of amoebiasis, took up the treatment of amoebic dysentery and its liver complications with emetine. Reports from all over the world now attest the value of this drug in the treatment of the acute manifestations of amoebiasis but unfortunately note the inefficacy of this treatment on the encysted forms of amoebae.
It is usual to give from ⅓ to ⅔ grain of emetine hydrochloride, dissolved in sterile saline, by hypodermic injection into the subcutaneous tissues. Some now give as high as 1 grain daily for about ten days, but Vedder prefers ⅓ grain repeated 3 times daily. In these doses there is practically no nausea.
It was found by Baermann and Heinemann that subcutaneous injections of from 2 to 2½ grains daily caused indisposition and anorexia. The subcutaneous injections are less painful than the intramuscular ones.
Rogers has used emetine intravenously in doses of 1 grain without bad effect.
Vedder calls attention to the fact that the minimal fatal dose of emetine is several times less when administered to rabbits intravenously than when given subcutaneously, so that after seeing rabbits die with what was apparently centric paralysis immediately after intravenous doses of comparatively small amounts of emetine hydrochloride he would hesitate before administering 1 grain intravenously in a human case.
Levy and Rowntree think emetine should not be given intravenously except in extreme cases. Among ill effects of emetine they note peripheral neuritis. Kilgore has reported such cases where even wrist-drop was seen.
Low has treated cases successfully with keratin-coated tabloids of emetine hydrochloride, giving ½ grain every night. Vedder has not obtained satisfactory results with the drug by mouth.
Rogers considers that 15 grains of emetine is the fatal dose for an adult man and as there is possibly a cumulative action it would seem safer to continue the drug only for ten days and then later repeat the course of hypodermics. Of course emetine cannot cure the ulcerative lesions of amoebic colitis and as bacillary infections are apt to set in when damaged tissues are present and, as such infections do not yield to emetine, one must be prepared for failure in treatment of symptoms in such cases.
Recognizing the great importance of immediate treatment to prevent extension of the ulcerative process, as well as against abscess, the rule was adopted in the medical care of the English forces, in the Mediterranean, to give emetine so soon as a case of dysentery was seen, not waiting for a determination of etiology. The treatment ordered was 1 grain of emetine, hypodermically, every day for ten days, or ½[162] grain morning and evening for ten days. There must not be any intermission of a single day.
Before the introduction of emetine the usual treatment was with ipecac.
It was customary to give 20 to 50 grains of powdered ipecac in capsule, cachet or keratin-coated pills to a patient with an empty stomach and who had had a dose of morphine or laudanum about 20 minutes before the time for giving the ipecac. The salol-coated ipecac pills are generally used in America. The patient should be in bed and should try to yield to the soporific influences of the opiate. Any flow of saliva should be removed with gauze as its swallowing would provoke nausea. Some use a mustard poultice to the epigastrium. It is remarkable the change which this treatment will effect in the number and character of the stools.
Many now think it advisable to give emetine hypodermically to reach the amoebae deeply seated and, at the same time, to give ipecac by mouth to destroy more superficially situated ones, or those in the lumen of the gut. Alcresta ipecac has been recommended as a good method of giving ipecac by mouth.
We do not have now the same confidence in emetine injections that we formerly entertained. In Egypt the combination of emetine injections with ½ grain keratin coated tablets of emetine by mouth seemed to give better results in the more chronic stages of amoebiasis.
Very favorable reports have come from the use of emetine bismuthous iodide. This drug is given by mouth in doses not exceeding 3 grains in a day. It is put up in gelatine capsules and a course of treatment is one 3 grain capsule each night for 12 nights. It is supposed that there is no action on the drug in the stomach as it is insoluble in dilute acid but as a matter of fact nausea and vomiting frequently occur and slight purging is common after its administration. During the twelve-day course of treatment the patient should remain in bed and be given a milk diet.
We have recently had success with the administration of ipecac by the duodenal tube and it might be that bismuthous emetine iodide could be given in the same way.
Ross thinks that the flushing action of salines, thus washing away amoebae and necrotic material, is of advantage in amoebic as well as in bacillary dysentery. He also thinks liquid petrolatum of value. Some advise the bismuth treatment recommended by Deeks of giving a large teaspoonful of bismuth subnitrate, in a glass of water, 3 or 4 times during the day.
A decoction made by boiling for 15 minutes one teaspoonful of powdered chaparro in 8 ounces of water and given one-half hour before each meal has been reported on favorably. The powdered roots, stems[163] and leaves of “Chaparro amargosa” are used. This is a plant of Texas and is named Castela nicholsoni. A decoction of about one-half strength of that taken by mouth is recommended for enemata. Simaruba bark is recommended by some practitioners. Its action is similar to chaparro. Benzyl benzoate is recommended for the pains and tenesmus of amoebic dysentery as well as bacillary dysentery. Twenty drops of the 20% alcoholic solution are given three times daily.
Many drugs have been recommended for colon irrigation of which the favorite is probably quinine muriate in dilution of 1 to 1000 or 1 to 2500. Inject 2 or 3 pints slowly by gravity. Protargol in 1 to 500 solution is better than silver nitrate in 1 to 2000. Emetine enemata do not seem to be of much value.
In very serious cases, particularly when gangrenous change in the mucosa may be present, the operation of appendicostomy seems indicated, following which a catheter is inserted and the large intestine irrigated with a 1% solution of bicarbonate of soda to wash away the mucus and later with a boracic acid solution of 1 to 125 or 1 to 10,000 of potassium permanganate.
In a discussion as to certain surgical considerations in connection with appendicostomy Muller notes that the right rectus incision is to be avoided on account of danger of gangrene from pressure of rectus on the stitched-up appendix. He also thinks that appendicostomy is much safer than caecostomy on account of the frequent thinning of the walls of the caecum. For irrigation he prefers a 1 to 500 solution of collargol.
In treating dysentery cases rest in bed and the use of a nonirritating diet are advisable.
The return of the increase of large mononuclears to normal may be used as an index to cure.
Walker and Emrich have recently reported success in treatment of cyst carriers by giving oil of chenopodium in 3 hourly doses of 16 minims, followed by castor oil and preceded by a dose of magnesium sulphate.
CHAPTER XI
LIVER ABSCESS
History and Geographical Distribution
History.—Although Hippocrates noted the method of evacuating abscess of the liver by caustics there was very little known about the condition until during the last century.
The history in connection with the finding of amoebae in liver abscesses is of very recent date (1887) and is taken up under the history of amoebic dysentery.
Geographical Distribution.—Concisely one may state that the distribution of liver abscess is in relation to the existence of amoebic dysentery. It is particularly prevalent in those centers of amoebic infection where there are many white men having little knowledge of the conditions necessary for the maintenance of health in the tropics.
In liver abscess, as with blackwater fever, it is education rather than acclimatization that brings about a diminution of these tropical diseases.
For several years subsequent to the American occupation of the Philippines amoebic dysentery and liver abscess were common but in more recent years liver abscess has become rare in Americans and amoebic dysentery much reduced in prevalence.
More temperate living results in less storing up of fat in the liver and an organ more resistant to infection.
Etiology and Epidemiology
Etiology.—The dislodgment of amoebae-containing material from amoebic intestinal ulcerations and the plugging of the portal capillaries by such emboli give us the starting point of a liver abscess. The exciting cause is Entamoeba histolytica which in the liver continues the same production of a gelatinous necrosis as is carried on in the submucosa of the large intestine or appendix.
This pathogenic amoeba is fully described under amoebic dysentery.
As to obtaining a history of amoebic dysentery in liver abscess cases we have the following statistics:
| 500 cases with dysentery findings in 60% | (Kartulis). |
| 444 cases with dysentery findings in 59% | (Zancarol). |
| 500 cases with dysentery findings in 85% | (Kelsch and Kiener). |
| 63 cases with dysentery findings in 90.5% | (Rogers). |
| 38 cases with dysentery findings in 85% | (Seamen’s hospital autopsies). |
Amoebic liver abscess is exceedingly rare among children and probably 10 times less common among women than men.
Of 40 cases of liver abscess Waring noted intemperance in 67.5% and authorities generally insist upon the importance of the abuse of alcohol as a predisposing factor.
Natives of India very rarely develop liver abscess but it has been noted that when they begin to follow the customs of Europeans, as to eating and drinking, such lesions become more common in them.
As to the proportion of cases of amoebic dysentery which give rise to liver abscess only the statistics of those who have differentiated between bacillary and amoebic dysentery are of any value. Such statistics would indicate that about 20% of the cases of amoebic dysentery are complicated by liver abscess.
Liver abscess may be present without demonstrable lesions in the large intestines, such lesions having healed or the intestinal involvement having been so slight as not to have caused other than microscopic changes.
It is a well-known fact that liver abscess may set in years after a patient has left the tropics and years after the occurrence of any dysenteric manifestations.
Pathology
There seems little doubt but that the amoebae in the thrombosed terminals of the portal vein are carried by way of the upward current into the liver where they lodge in the liver capillaries, Councilman and Lafleur having found amoebae in such emboli.
Another view is that the amoebae may wander across the abdominal cavity and enter the liver in this way. This seems as improbable as that view which considers a possible entrance by way of the bile duct. Bile is toxic to amoebae and it would be difficult to explain their presence in the small intestines.
In 639 cases Roux found the abscess in the right lobe in 70% of the cases.
Other statistics give about 75% for the right lobe, 10% for the left lobe, 4% for the lobus Spigelii and in about 10% of cases abscesses are found in both right and left lobes.
In 562 cases Zancarol found a single abscess in 60% of the cases.
In 288 cases Waring found a single abscess in 61.5%, double abscesses in 11.5% and multiple abscesses in 27%. The favorite site of liver abscess is the superior and posterior part of the right lobe and near its surface.
The abscesses vary enormously in size, some being no larger than a walnut while others may contain a quart or more of pus, exceptionally as much as a gallon. The pus is typically of a chocolate color and contains degenerated liver cells, granular débris and often haematoidin and Charcot-Leyden crystals. There is an absence of polymorphonuclears. It may however be creamy in color.
In Strong’s cases about 50% of the abscesses showed bacteria upon culturing, the organisms noted being staphylococci, streptococci, B. coli and B. pyocyaneus.
The walls of liver abscesses are rather shaggy and the amoebae are found deeply located.
It is probable that the necrotic process, set up by the amoebae, begins in the interlobular capillaries although it may at times begin within the lobule.
Microscopically, the necrotic abscess wall shows amoebae in its depths but necrosis of the surrounding tissue beyond the zone of the amoebae is noticeable which would suggest the elimination by the amoebae of some toxic substance. There is an absence of polymorphonuclear infiltration around the abscess.
Surrounding the abscess wall there is a zone of marked hyperaemia. Amoebae may be found in this area as well as in the abscess wall.
If the liver abscess is not treated by emetine or with this drug and some surgical procedure the tendency is for rupture to occur and Cyr’s statistics show that of 159 cases rupture occurred as follows: lungs 59, pleural cavity 31, peritoneal cavity 39, intestines 8, stomach 8, vena cava 3, kidneys 2, bile ducts 4, pericardium 1 and externally 2.
Symptomatology
Although the statistics would indicate that a history of amoebic dysentery has been obtained in only from 60 to 90% of cases of liver abscess, yet, when we consider that amoebic lesions of the large intestines have been frequently noted at autopsy in those who had never shown symptoms of dysentery during life, we are forced to believe that amoebic lesions of the appendix or large intestines are necessary factors in the production of liver abscess. Consequently, a history of amoebic dysentery is one of the most important points to consider in the making of a diagnosis of tropical liver abscess.
Tropical Liver.—There is also much evidence to be obtained from statistics and otherwise to support the view that the amoebic infection of the liver is only possible in a person whose liver has been functionally impaired. To this condition the designation tropical congestion of the liver or simply tropical liver has been applied. There is much to support the view that, in the tropics, the intestines and liver take the place of the thoracic organs in being subject to congestion. In temperate climates excesses and exposure to debilitating influences result in coryza or pneumonia. In the tropics we have diarrhoea and congestion of the liver. Tropical[167] liver is recognized by vague digestive troubles, high-colored urine, loss of energy, irritability, with a sensation of fullness in the region of the liver which is generally described by the patient’s statement that he feels his liver. There may be pain referred to the right shoulder and the liver may be tender on palpation.
By the discontinuance of alcohol and highly spiced foods, with treatment by phosphate of soda or sodium sulphate, together with general care of the health, the patient may recover completely.
Rogers recognizes a condition which he terms the pre-suppurative stage of amoebic hepatitis in which the amoebae from dysenteric lesions have lodged in the portal terminals of the liver but in which abscess formation has not taken place.
At this stage we have a leucocytosis in which the polymorphonuclears are but little increased in percentage with a low remittent fever. At this time Rogers considers that the disease may be cured by emetine or ipecac and liver abscess avoided.
A Typical Case of Liver Abscess.—Following a case of amoebic dysentery, during the period of convalescence or subsequently, a rather irregular type of fever is noted, which shows an evening rise with sweatings which tend to become colliquative. From a marked feeling of weight in the region of the liver there may later develop tenderness or pain upon palpation of the liver. Of importance is the fact that there is no associated splenic enlargement. In the majority of cases the right side of the liver enlarges in an upward direction. A tape-measure will often show enlargement of the right side. Pain referred to the right shoulder is often complained of when the abscess is located in the upper convex part of the liver but, when nearer the inferior concave surface, there may be pain referred to the region of the appendix. When located in the left lobe the symptoms may be considered as of gastric origin.
The upward enlargement of the liver as shown by X-rays is of great value in diagnosis, but an abscess located in the center of the liver is not indicated by such rays.
There is a marked tendency to splint the liver so that the patient tends to lie towards the right side and when walking applies his right arm and forearm to his side, which led Koch to remark, “It is as if he carried his abscess under his arm.” The right rectus often shows rigidity.
Auscultation of the base of the right lung reveals a moist crepitation which, together with a dry cough (tussis hepatica), the fever, evening sweats, anaemia and emaciation, may suggest tuberculosis. The respirations are shallow as deep inspiration tends to cause pain. It[168] must be remembered that cases of liver abscess have been reported where there were practically no symptoms.
Insomnia is a marked feature in many cases. Jaundice is rare, but an earthy color or subicteroid tinging is often noted. The superficial veins may be enlarged.
The urine is scanty and high-coloured, frequently with a marked increase in the ammonia nitrogen. Urobilin may be present in considerable amount.
There is a rather constant but low leucocytosis of from 12 to 20 thousand, which shows only about 70% of polymorphonuclears with an increase in large mononuclears up to 10 to 15%.
The final proof is the obtaining of the chocolate-coloured or anchovy sauce-like pus by exploratory puncture.

This pus does not contain pus cells but only granular débris, cholesterin crystals and is often bacteriologically sterile. The amoebae, being in the abscess wall, are not apt to be found when pus is at first withdrawn. Owing to the tendency of liver abscess to rupture into the lungs the first indication of the true nature of a prolonged hectic fever may be obtained when the characteristic pus is expectorated by the patient.
Attended with progressive emaciation and exhaustion the patient, as a rule, after a prolonged illness, dies, unless operative procedures cure him or some intercurrent disease brings about his death.
Symptoms in Detail
Onset and the Fever Chart.—The onset is at times so insidious that there may be no symptoms and yet a liver abscess be found at autopsy. Usually following convalescence after amoebic dysentery an irregular fever sets in which becomes hectic in character. Profuse sweats accompany the evening rise. The morning temperature is frequently normal and there may be frequent apyretic intervals.
The Respiratory System.—Crepitation at the right base, a dry cough (tussis hepatica) and shallow respirations are features of the disease.
The Nervous System.—Pains in the right shoulder are connected with irritation of the branches of the phrenic nerve.
The patient is irritable and often complains of insomnia.
The right rectus tends to be somewhat rigid and decubitus is dorsal or toward the right side.
The Liver and Spleen.—The liver is tender and as the abscess in nine-tenths of the cases is located in the right lobe and generally toward the upper convex surface we have an enlargement upward. There is very rarely any jaundice.
The urine shows an excess of urobilin and of nitrogen eliminated as ammonia. When the abscess is in the left lobe the condition is apt to be considered as some gastric disturbance. The spleen, as a rule, shows no enlargement.
Examination of the Blood.—There is usually a moderate leucocytosis with normal polymorphonuclear percentage and increase in the large mononuclears.

Diagnosis
Clinical Diagnosis.—Of greatest importance is a history of a previous dysentery although it must be remembered that liver abscess may appear in one who has never had dysenteric symptoms. Fever of a hectic type with crepitation at right base, pain and upward enlargement of the liver are most significant.
The X-ray may confirm the diagnosis of upward enlargement which may be as high as the angle of the scapula. The majority of conditions causing enlargement of the liver give a downward enlargement.
The amelioration of symptoms by giving emetine hypodermically for two or three days is diagnostically exceedingly important.
Syphilitic gummata may give the picture of liver abscess, especially as regards the fever and loss of weight. Iodide of potash is said to be of use in differentiating, as it controls the fever of syphilis. The gummatous enlargement, however, is irregular and projects downward.
Suppurative pylephlebitis generally arises from infections of the colon or appendix. This condition as well as pyaemic (multiple) abscesses of the liver is apt to show jaundice.
In suppurative cholangitis and cholecystitis we get a history of biliary colic, jaundice and usually a marked point of tenderness at the tip of the ninth rib and a tumor in the region of the gall bladder. Abscess of the left lobe may give the symptoms of gastric trouble.
In differentiating empyema we usually have a history of pleurisy or pneumonia.
Suppurating hydatid cyst which may be confused with liver abscess is most surely differentiated by finding echinococcus hooklets.
Then too the complement fixation test for hydatid disease will differentiate.
Tuberculosis is often thought of, particularly when a liver abscess ruptures through the lungs. Malaria is also usually suspected. Abscess in the kidney or perinephritic region may be very confusing. In an abscess of the abdominal wall an exploring needle does not move up and down with respiration as it does when penetrating a liver abscess cavity.
Laboratory Diagnosis.—The chocolate-colored pus of a liver abscess, when there has been no bacterial contamination, shows an absence of polymorphonuclears and does not at first show amoebae. These appear in the pus coming from the drainage tube about the third day. Cholesterin and haematoidin crystals may be found in the granular débris of a fresh drop of pus used for examination for amoebae.
Liver abscess usually shows a moderate leucocytosis with a normal polymorphonuclear percentage and an increase of large mononuclears and transitionals to about 12 to 20%.
According to Schilling-Torgau we may have a perfectly normal white count and polymorphonuclear percentage and yet have evidence of the presence of liver abscess in his modification of Arneth’s index, so that in an apparently normal differential count we may find that ½ or more of the polymorphonuclears are of a less mature type and in cases where there are many immature polymorphonuclears we have indications which force a very cautious or unfavorable prognosis.
Thus a differential count of 33% band-form polymorphonuclears and 39% of normal nucleated ones would make us give a cautious prognosis, while one with 1% myelocytes, 22.5% immature polymorphonuclears, 21% band-form nucleated ones[171] and 30% of normal ones would make for a very bad prognosis. We have a displacement to the left. Normally there are 63% of normal polymorphonuclears, 4% of band-form and no immature ones or myelocytes.
One may find an iodophilia in liver abscess.
Of the functional liver tests we may determine the ammonia quotient, the percentage of N eliminated as ammonia being increased in abscess of the liver. The same is true of the lipase test. Probably the most specific test for disturbances of the hepatic function is that for urobilinogen. The test is made by adding 5 to 10 drops of Ehrlich’s aldehyde reagent to 5 cc. of perfectly fresh urine when a positive reaction gives a fine cherry-red color.
Prophylaxis and Treatment
Prophylaxis.—The prophylaxis is the same as that for amoebic dysentery plus avoidance of anything which reduces the functional power of the liver, such as overfeeding, alcoholic excesses, etc.
It is well to remember that abscesses may occur months or even two or three years after an attack of amoebic dysentery, consequently it is well to give a grain of emetine on two or three successive days of each month following an acute attack.
Treatment.—Leaving out of consideration the pre-suppurative stage of amoebic hepatitis which, according to many authorities, responds to injections of emetine, it may be stated that the treatment of liver abscess is entirely surgical and such treatment should be instituted the moment the diagnosis is made. The earlier a liver abscess is drained the less run down will be the patient, the more rapid the convalescence and the better the prognosis.
Until recently surgical authorities condemned severely the trocar and cannula method of operation, but with the introduction of emetine there are now those who believe that such a procedure may suffice and a more radical operation not be necessitated.
Prior to introducing the trocar and cannula the usual procedure is to use an aspirating needle of about ⅛ inch bore and 3½ inch length. If the needle happens to be longer it should not be passed deeper than 3½ inches, in a person with a 32-inch chest, in order surely to avoid the vena cava. If there are no distinct localizing signs the needle should first be introduced in the eighth or ninth interspaces in the anterior axillary line and pushed backward, inward and slightly upward. Manson recommends at least 6 punctures before abandoning exploration. Cantlie does not think that a moderate degree of haemorrhage from the puncture of the liver will do harm in a case which is simply a liver congestion. One should always be ready to operate in case pus be found in the exploring needle. Leaving the needle in situ a small skin incision is made and a 4 or 5 inch by ⅜ inch trocar and cannula introduced along the line of the needle. Withdrawing the trocar some of the pus is allowed to escape through the cannula and there is then introduced a 6 × ½ inch piece of strong[172] rubber drainage tubing, one end of which has lateral fenestrations but a closed tip in order that a long steel pin may put the tubing on the stretch so that it passes the smaller lumen of the cannula.
The cannula is then slipped out over the tubing and the external stretched end of the tubing released so that the contracting rubber fills the puncture. The steel pin used for introducing the rubber tube is then withdrawn and the tubing transfixed close to the skin with a safety pin.
After the cavity has drained of pus a dressing is applied. There are some who advocate aspiration alone without subsequent drainage. The dressing should be changed frequently and a connecting tube, draining into an antiseptic-containing bottle, should be attached to the tube in the cavity in order to obtain a syphoning action. Some aspirate and inject into the cavity about 2 ounces of 1 to 1000 emetine solution.
Some report favorably from the use of 1 to 1000 quinine irrigations. At present the hypodermic use of emetine will probably obviate the necessity of any irrigation.
There are those who think that a preliminary aspiration, followed by incision, after a few days of improvement in general condition, is the best method in serious cases.
It is usual to recommend a general anaesthetic when introducing the aspirating syringe or trocar and cannula. Local anaesthesia with quinine and urea hydrochloride, however, will usually suffice and lessen the dangers of shock in bad cases. Rib resections and even intra-abdominal procedures are best done under local anaesthesia provided the operator is familiar with the technic.
Newman has recently warned against the use of the small aspirator for diagnosis, pointing out that it is unreliable and that the diagnosis should be made by other diagnostic aids, including hypodermic use of emetine. He notes the occurrence of death from internal haemorrhage, the interference of the needle with the surgical incision and, further, the obscuration of the field of operation by pus where no adhesions exist and, finally, the danger of general peritoneal infection from a leak. He notes that the cavity may be under tension and that the pus may force itself along the track of the needle. He recommends incision and packing with gauze where adhesions do not exist and the exploration of the liver with dressing forceps instead of cutting into the liver with the knife.
Usual Operation for Liver Abscess
Either a vertical incision about the middle of the right rectus (Bevan) or a Kocher incision, parallel with the costal margin, may be used. The latter incision favors hernia if prolonged drainage is required. The hand is introduced into the abdominal cavity and the liver palpated. Often the borders of the site of a liver abscess give a hard feeling on palpation. If adhesions are not present the area should be packed off with gauze and the cavity opened by a dressing forceps, haemostat or thermo-cautery. It is often advisable to introduce a trocar and cannula and to drain off the excess of pus.
Where the abscess is situated far back or high up in the liver the transpleural route is to be preferred to the abdominal one. Make a 3 or 4 inch incision over the 9th rib with its center in the line of the angle of the scapula. Excise about 2 inches of rib subperiosteally. An assistant presses a roll of gauze against the tissues above the line of incision to prevent air entering the pleural cavity. Later the upper flap may be sutured to the endothoracic fascia. Even if the pleural cavity should be opened and air enter no serious result will follow although it is an accident to be avoided if possible. The diaphragm is now cut through and the liver exposed and after packing gauze around the area to be opened, the abscess cavity is entered and drained as previously described.
McDill prefers to resect 2 or 3 inches of both 9th and 10th ribs in the midaxillary line. The muscle wounds made in resection are then closed by catgut. This movable wall is now forced against the diaphragm with a roll of gauze pressed inward by an assistant. A 3-inch incision is now made through this bone-free wall near the upper border of the 11th rib, going through diaphragm and exposing the liver. The edges of the wound in the thoracic wall and diaphragm are now clamped together by haemostats to close off the pleural cavity. Later catgut sutures are substituted for the forceps. The liver often bulges into the wound. Finding the abscess by a palpating finger as a rather firm area in a less resistant liver surface we introduce a forceps or aspirating needle or trocar and proceed as above noted.
There are indications that the use of emetine subcutaneously may make the more radical operations unnecessary. In a recent symposium on liver abscess many of the papers would indicate a preference for aspiration without drainage coupled with emetine subcutaneously.
Rogers, in a recent article, notes that a case of liver abscess was cured by emetine without any form of operation. Recent experience, however, would indicate that it is necessary to evacuate the pus to effect a cure.
SECTION II
DISEASES DUE TO BACTERIA
CHAPTER XII
BACILLARY DYSENTERY
History and Geographical Distribution
History.—Epidemics of dysentery have been noted since ancient times, the widespread and fulminating nature of such outbreaks in times of war and famine having impressed observers in all ages. The disease is mentioned in the Ebers Papyrus (1600 B. C.).
Herodotus referred to an epidemic of dysenteric nature in the Persian Army and Hippocrates described the dysenteric syndrome. It has been known in India since remote times.
While the etiology of amoebic dysentery was thoroughly investigated and its connection with amoebae fairly well established during the decade from 1880 to 1890 it was not until 1898 that Shiga isolated the causative organism of bacillary dysentery. It is true that Chantamesse and Widal drew attention to a bacillus isolated from large intestines, mesenteric glands and spleen of cases of tropical dysentery but the organism was not clearly differentiated from Bacillus coli. Celli isolated an organism which coagulated milk and produced gas in glucose media. This organism which Celli called B. coli dysentericus, differs culturally from B. dysenteriae.
Geographical Distribution.—Bacillary dysentery differs from the amoebic form in that it tends to appear in extensive epidemics spreading over temperate as well as tropical and subtropical parts of the world.
It is peculiarly liable to follow the movements of armies in any part of the world and like typhoid fever its distribution is one of hygienic rather than geographical influence.
Infections with various strains of dysentery bacilli are important factors in morbidity among infants and young children in whatever part of the world the question has been investigated. The disease is prone to prevail in lunatic asylums whether in temperate or tropical parts of the world.
Etiology and Epidemiology
Etiology.—During a very fatal epidemic of dysentery in Japan Shiga isolated an organism, Bacillus dysenteriae, from dysenteric stools of 36 cases, which bacillus he found to be agglutinated by the serum of the patients. He reported this work in 1898. In 1900, Kruse isolated an organism from patients in an epidemic of dysentery in Germany which corresponded to that of Shiga. In 1900, Flexner, Strong and Musgrave, working in Manila, not only encountered an organism similar to that of Shiga but also an organism of wider fermentative action. Dysentery has resulted from accidental laboratory infections and Strong produced dysentery in a prisoner condemned to death through ingestion of cultures.
In 1903, Hiss and Russell isolated an organism from a fatal case of diarrhoea in a child to which they gave the name “Y”.
On the whole, dysentery bacilli correspond culturally with the typhoid bacillus except in showing slightly weaker fermentative action on carbohydrates. The main point of difference however is their absolute nonmotility.
The characteristic of nonmotility is of greatest differentiating value and the reports of slight motility are probably from misinterpretation of molecular movement as motility. The dysentery bacilli do not form those thread or whip-like filaments so characteristic of typhoid cultures and are somewhat plumper. The dysentery bacillus is not found in the blood and hence is not eliminated in the urine, although recently there have been reported rare cases where dysentery bacilli were isolated from the blood. It is found in mesenteric glands. In dysentery patients agglutination phenomena do not show themselves until about the tenth day from the onset. Hence, this procedure is of no particular value in diagnosis. It is of value, however, to identify an organism isolated from the stools at the commencement of the attack, using serum from an immunized animal or a human convalescent for the agglutination test.
There seems to be only moderate agglutination power in the serum of convalescents from Shiga strains. Flexner strains give higher agglutinations, but early in convalescence the serum is not apt to have a titre of more than 1-150.
Dysentery bacilli produce a coagulation necrosis of the mucous membrane of the large intestine and occasionally of the lower part of the ileum. Polymorphonuclears are contained in the fibrin exudate.
It was formerly thought that these lesions were of local origin, but the present view is that toxins are produced which, being absorbed, are eliminated by the large intestine with resulting necrosis. Flexner, by injecting rabbits intravenously with a toxic autolysate, produced characteristic intestinal lesions. The toxin withstands a temperature of 70°C. without being destroyed. The toxin may cause joint trouble.
There are two main types of dysentery bacilli:
1. Those producing acid in mannite media—the acid strains (Flexner-Strong types).
2. Those not developing acid in mannite (Shiga-Kruse types). The Shiga type is very toxic in cultures, while the Flexner type seems to be less so. An organism resembling the Shiga bacillus but producing indol is the Schmitz bacillus. It does not appear to be pathogenic.
In immunizing horses for the production of antidysenteric serum it is customary to use both Flexner and Shiga strains, thus producing a polyvalent serum.
Lentz recognizes 4 types of dysentery bacilli for the differentiation of which he uses mannite, maltose and saccharose bouillon with litmus as an indicator.
| Shiga-Kruse | Flexner | Strong | “Y” | |
| Mannite | Blue | Red | Red | Red |
| Maltose | Blue | Red | Blue | Blue |
| Saccharose | Blue | Blue | Red | Blue |
The following table gives the more important cultural characteristics of the intestinal bacilli which might be confused with the various strains of dysentery bacilli.
B - Milk coagulation
C - Glucose
D - Maltose
E - Lactose
F - Mannite
G - Saccharose
H - Glucose neutral red bouillon
I - Butt
J - Slant
K - Indol
| Litmus Milk |
Russel’s Medium |
||||||||||||
| A | B | 1st day | 3d day | C | D | E | F | G | H | I | J | K | |
|---|---|---|---|---|---|---|---|---|---|---|---|---|---|
| B. faecalis alkaligines | + | - | Alk | Alk | O | O | O | O | O | O | O | O | - |
| B. typhosus | + | - | A | A | A | A | O | A | O | O | A | Alk | - |
| B. dysenteriae (Shiga-Kruse) |
- | - | A | Alk | A | O | O | O | O | O | A | Alk | - |
| B. dysenteriae (Flexner-Strong) |
- | - | A | Alk | A | A | O | A | O | O | A | Alk | - |
| B. dysenteriae “Y” | - | - | A | Alk | A | O | O | A | O | O | A | Alk | + |
| B. Morgan No. 1 | + | - | O | O | A G | O | O | O | O | G | .. | .. | + |
| B. paratyphosus A | + | - | A | A | A G | A G | O | A G | O | G | A G | Alk | - |
| B. paratyphosus B | + | - | A | Alk | A G | A G | O | A G | O | G Fl | A G | Alk | - |
| B. enteriditis (Gaertner.) |
+ | - | A | Alk | A G | A G | O | A G | O | G Fl | A G | Alk | - |
| B. coli | + | + | A | A | A G | A G | A G | A G | O | G Fl | A G | A | + |
| B. lactis aerogenes | - | + | A | A | A G | A G | A G | A G | A G | G Fl | A G | A | - |
| B. cloacae | + | + | O | A | A G | A G | A G | A G | A G | G Fl | A G | Alk | + |
| B. proteus vulgaris | + | .. | O | Alk | A G | A G | O | O | A G | G | A G | Alk | - |
Of the above tabulated nonspore bearing, Gram-negative, intestinal bacilli only B. lactis aerogenes shows capsules and only B. cloacae and B. proteus vulgaris liquefy gelatin. In the table + = positive, - = negative, O = no change, A = acid, Alk = alkaline, G = Gas and Fl = fluorescence in neutral red bouillon.
Epidemiology.—There is probably no disease, with the possible exception of cholera, where those attending a patient are so liable to have their hands contaminated with infectious material.
The terrible frequency of the stools and the tendency of the mucilaginous mucoid mass to become smeared over the buttocks and clothing of the patient make it onerous for an attendant to carry out methods of personal protection. In a family, where the mother may have to care for a sick child, and prepare food for the other children and herself, the opportunities for the spread of the infection in the family are great.[178] In military barracks, as well as in other institutions where large numbers make use of the same water-closet accommodations, the chances of contamination of the seat by a patient responding to the frequent and imperious demands for evacuation are most probable, with subsequent transference of the infectious material to others. Bacillary dysentery is peculiarly an institutional disease and tends to spread in jails, orphan asylums and the like. A carrier is a particular source of danger in such an institution.
Not only is there the danger from a patient ill with bacillary dysentery but as well that from the convalescent or chronic carrier. Such carriers are particular sources of danger where they take part in the preparation of food for others. It is now thought that the striking prevalence of the disease in insane asylums is associated with the difficulty of making such patients observe the proper care of their hands as well as their persons.
Friedmann has recently noted an outbreak of dysentery due to the Shiga type of bacillus which was instituted by a soldier returning to the barracks from a furlough.
There resulted 86 cases in the man’s regiment of which 49 belonged to his own squadron. The spread of the disease was traced to the latrines. The epidemic was suppressed by the enforcement of the most rigid rules of cleanliness especially as regarding washing of the hands after leaving the latrines.
The stools of the convalescents were examined and no man was discharged from hospital until his stools were negative for dysentery bacilli upon 3 successive tests in fourteen days.
Isolation of the bacilli from convalescents was obtained in 40 patients only for periods under fourteen days while with 27 others such carrying of bacilli lasted from two weeks to one month.
As the dysentery bacillus does not invade the blood stream we do not find it in the urine so that to a certain extent the dysentery bacillus carrier is less dangerous than the typhoid one.
There have been reports of isolation of Flexner and “Y” type bacilli from monkeys and rabbits but there is nothing to indicate that any other host than man is of importance.
Flies are undoubtedly of as much importance in the spread of bacillary dysentery as of typhoid.
The possibility of infection through the medium of soiled clothes, sent out for washing, is to be thought of.
There have been several instances of transference of the disease by the water supply.
In times of war, with large forces of soldiers, bacillary dysentery tends to become the most important disease encountered by military[179] surgeons. During the Civil War there were 285,000 cases of dysentery in the Federal army.
It is possible that infectious material may be disseminated as dust and thus contaminate food.
Pathology
Injection of dysentery bacilli into the peritoneal cavity of guinea pigs causes a muco-sanguinolent diarrhoea with congestion of and haemorrhage into the caecum. There is also a haemorrhagic peritoneal exudate.
In the rabbit lesions similar to those in man are obtained as well as paralysis of the limbs.
It is therefore thought that there are two toxins concerned in the pathology of bacillary dysentery, one a neurotoxin which may cause a peripheral neuritis or joint trouble and the other a toxin which acts on the lower bowel, especially the caecum, with the production of congestion and coagulation necrosis of the mucosa.
Cases have been reported where the adrenals showed congestion and necroses, as if subjected to the action of a toxin.
In man we have an acute inflammation of the mucosa of the large intestines and, in the tropics, we frequently find the lower third of the ileum involved as well. In amoebic dysentery the process rarely extends beyond the ileo-caecal valve. A catarrhal process with hyperaemia and sero-purulent exudate is first noted, to be succeeded by fibrin formation in the mucosa, a process of coagulation necrosis. When the process invades the ileum there is no involvement of Peyer’s patches. Virchow noted the greater intensity of the process in the region of the rectum, sigmoid flexure and ileo-caecal valve.
As a rule, however, the entire large intestine is grayish red, looking like lustreless red velvet. Later on we may have irregular islands of grayish membrane formation surrounded by the red swollen congested gut. The solitary glands are usually swollen and may soften and ulcerate, having the submucosa as a base. Ulceration in bacillary dysentery is superficial rather than deep as with amoebic dysentery. The ulcers of bacillary dysentery involve the free folds of the intestine and extend transversely while amoebic ulcers run longitudinally. The intervening mucosa is unaffected in amoebic ulcerations while in bacillary ones it is inflamed.
Microscopically we note marked congestion of the blood vessels of the mucosa and submucosa with dilated lymph spaces full of polymorphonuclear cells.
In the mucosa we find an outpouring of pus cells which are entangled, along with the glandular structures of the mucosa, in a fibrinous exudate which causes necrosis of the mucosa (coagulation necrosis).
In chronic bacillary dysentery, according to Rogers, the lesions are limited to the lower portion of the large gut and rarely extend above the descending colon.
In this region one finds serpiginous ulcerations separated by islands of mucosa. Willmore and Savage have noted autopsy findings of what was practically a large granulating surface over the whole large intestine, in cases which had apparently recovered, with the exception of a prolonged convalescence.
Symptomatology
Bacillary dysentery usually runs an acute course, rarely relapsing and but occasionally going on to a chronic condition. The period of incubation is usually from two to seven days although accidental infection with bacilli in the laboratory has given an incubation period approximating twenty-four hours. Periods of incubation longer than a week can probably be explained as for cholera, such cases being in those who are healthy carriers, but by reason of some gastro-intestinal upset the quiescent bacilli take on pathogenic activity.
In temperate climates and in particular when the infecting organism is a Flexner type the case may appear as a watery diarrhoea associated with colicky pains and anorexia. The stools soon become more scanty in amount, frequent in number and associated with straining. This is followed by mucous stools more or less tinged with blood. The temperature is normal or but slightly elevated and the patient does not seem ill.
In the tropics and in temperate climates where the Shiga type bacillus is the infecting organism the onset is usually rather sudden with malaise, abdominal pain and a diarrhoea, which only temporarily relieves such pain. This initial diarrhoea is soon followed by the characteristic dysentery stool and the pains, which latter tend to centre about the umbilicus and to become continuous. There is usually loss of appetite and slight nausea and the patient may at times show a very slight tendency to flightiness. The mind however is usually clear. Fever of moderate degree is not uncommon and it may be quite marked,—up to 104°F. Ingestion of food or drink or any movement of the body brings on a desire for defecation.
The number of stools, which in mild cases number 15 to 30, may become excessive, even more than one hundred in twenty-four hours, and the tenesmus most torturing, so that excoriations around the anus and at times prolapse of the bowel intensify the distressing clinical picture. In acute cases the stool may be almost pure blood with only an admixture of mucus.
Vesical tenesmus may be present and the urine may be diminished in amount.
There is a toxic effect on the heart so that the pulse tends to become accelerated and weak. Bacillary dysentery may show a moderate[181] leucocytosis with increased polymorphonuclear percentage instead of a large mononuclear one as with amoebic dysentery.
At times, however, the lymphocytes may be the leucocytes showing the greatest relative increase.
Collapse Types.—In the most severe types of dysentery we may have an abrupt onset with rigors and vomiting and a high fever. This fever gives way to a subnormal temperature and the patient shows signs of collapse and such a case may die without having passed dysenteric stools. The abdomen is rigid and very tender on palpation.
Entero-dysentery.—In those cases where the process extends to the lower portion of the small intestine the general symptoms are much more severe although the tenesmus is less and the stools less frequent and more voluminous. They contain much blood and mucus mixed with feculent material. Shiga calls such cases entero-dysentery.
In severe cases of the more typical dysentery or colodysentery, as designated by Shiga, the stools may change from the mucopurulent mass to a serous discharge which is very rich in albumin and of an albuminous odor. In such cases emaciation of the patient is very rapid. Such cases may show signs of collapse with cold clammy skin and the clinical picture one associates with cholera.
It has been suggested that such cases may be due to action of the dysentery toxins on the adrenal.
This serous fluid may contain the flesh-like particles which the French liken to gut scrapings. During convalescence there may be an arthritis, which however does not impair the function of the joint.
Complications.—In addition to the arthritis there may be neuritis, which, in severe cases, may go on to muscular atrophy. In the arthritis the knee joint is that most frequently involved. This complication appears late in the course of the attack. Arthritis may be frequent in one epidemic and absent in another. The joint swelling usually clears up completely. Some of the reported joint involvements are undoubtedly serum reactions from antidysenteric serum treatment. Rarely in Shiga infections we may have an irido-cyclitis. Subnormal temperature may follow severe attacks.
In some epidemics of dysentery gangrenous manifestations have been common. This is a very fatal type and is recognized by the passage of dark-brown serous discharges containing ashy gray to black sloughs or even tubules of gangrenous mucosa, the stool having a putrid odor. The general symptoms are pronounced, there being a dry glazed tongue, and low muttering delirium with a thready pulse. It is the typhoid state.
It is usual to consider bacillary dysentery as a self-limited disease, running on to convalescence within ten days or two weeks.
Rogers has called attention to the importance of bearing in mind a chronic condition as well as the acute one. In these chronic cases the ulcerations are usually located in the descending colon, sigmoid flexure or rectum and give rise to frequent stools containing blood and mucus and causing a progressive loss of strength and weight. There is marked digestive disorder and the patient becomes weak, anaemic and neurasthenic.
Diagnosis
In the presence of the dysenteric syndrome of tormina, tenesmus, frequent scanty stools of muco-purulent or muco-sanguinolent character, one must keep in mind the various conditions which may give rise to such manifestations of dysentery and not diagnose a bacillary dysentery until we have excluded tuberculous, cancerous and syphilitic processes as well as those connected with schistosome or other helminthic infections.
Clinical Diagnosis.—Amoebic dysentery is differentiated clinically from bacillary dysentery by the usual absence of manifestations of toxaemia and by its insidious onset and chronic course.
It is important however to remember that either bacillary or amoebic dysentery may show gangrenous manifestations and in such cases the clinical picture of the typhoid state is the same whether the process is amoebic or bacillary. Fulminant bacillary dysenteries may greatly resemble cholera in its algid stage.
Tropical liver abscess is a complication exclusively occurring in the amoebic form of dysentery while joint manifestations and evidences of multiple neuritis may be noted in some epidemics of bacillary dysentery. Again, the toxins of the dysentery bacilli have a tendency to damage the myocardium. At present we consider the good effects of the administration of emetine as important in the diagnosis of amoebic dysentery.
It is important to remember that chronic dysentery may result from bacillary as well as amoebic infections, although a chronic process is more a feature of amoebic dysentery.
The muco-purulent stool of bacillary dysentery is more of a milky whiteness and flecked or streaked with blood or a very viscous bright blood-tinged mucus rather than the homogeneous, grayish brown, gelatinous mixture of disintegrated blood and mucus of the amoebic one. The odour is apt to be foetid in amoebic stools but rather albuminous with bacillary dysentery ones.
Laboratory Diagnosis.—The chief point is to determine whether we are dealing with an amoebic or bacillary infection. While these two kinds of dysentery may coexist it is practical to consider a case in which amoebae with long, rapidly extruded, finger-like pseudopodia and containing red blood cells are found, as one of amoebic dysentery.
A fresh specimen of the muco-purulent stool of bacillary dysentery shows, in addition to pus cells, numerous large, phagocytic cells, which may show vacuolation and strikingly resemble amoebae. Such cells never show motility but, under conditions of lowered temperature of specimen or from prolonged standing and beginning disintegration, the amoebae too fail to show motility. If mounted in Gram’s iodine solution these large cells show a much larger nucleus than that of amoebae and take the yellow staining of iodine more intensely. The best method, however, is to make a smear, fix it by heat and stain by Gram’s method or with Loeffler’s blue or dilute carbol fuchsin. These confusing cells stain easily and perfectly and in the Gram specimen we note the Gram-negative bacilli in the cytoplasm. Giemsa’s stain, with methyl alcohol fixation, or the usual Wright or Leishman technique answer equally well. On the other hand it is rather difficult to obtain satisfactorily stained amoebae in this way, it usually being necessary to fix moist thin smears of the stool with some bichloride fixative, as Zenker’s fluid, and then carry out the staining with haematoxylin.
The Stained Smear.—The presence of pus cells as well as endothelial cells in a stained smear of material from a bacillary dysentery stool is of value in differentiating from an amoebic stool smear in which pus cells are rarely seen. The amoebic dysentery smear gives more the picture of granular débris.
We should always examine a stool as soon after it is passed as possible.
If the microscopical examination indicates a bacillary infection we should take a small mass of the stool, wash it in sterile water and then drop it in a tube of sterile bouillon or salt solution. After emulsifying in this tube of bouillon we take up 2 or 3 loopfuls of the emulsion and deposit them on a poured plate, later smearing out with a glass rod, either by successive parallel strokes or by revolving the plate while smearing the surface with the glass rod. It is in the first two or three days of an attack of acute dysentery that we obtain the best cultural results, often noting a pure culture of dysentery bacilli from proper material taken at the onset. Manson-Bahr states that he has never recovered true dysentery bacilli from a purely faecal stool. Even faecal contamination of the mucoid mass makes it difficult to recover the organism. Dysentery bacilli rapidly die out if the stool is acid so that it has been recommended to make the stool strongly alkaline where it has to be sent to a laboratory from a distance.
It has seemed to me that litmus lactose agar gives results more surely than the more restraining faeces-plating media. Still I generally use Endo’s fuchsin agar because it is always at hand for typhoid or paratyphoid culturing and gives good results. The dysentery bacillus colonies on this medium are like those of typhoid—grayish white. In England they prefer MacConkey’s neutral red bile salt agar[184] while others use the Conradi-Drigalski medium. We are now using the Teague medium, which is taken up in the chapter on Faeces. On all these media the colonies resemble those of typhoid and the differentiation is most easily made by examining for motility. At the same time one not infrequently finds lack of motility in bacilli from colonies just isolated on Endo’s medium which later on in subculture show motility and are found to belong to the typhoid or paratyphoid group. For the sure determination of dysentery bacilli or for differentiating the Flexner and Shiga strains one should carry out agglutination tests.
The isolation of dysentery bacilli from chronic cases or from convalescents is more difficult as a rule and agglutination tests may be more practical. A trouble is that an agglutinating effect may be connected with a prior infection.
Although some observers have noted the appearance of agglutinins in the serum of cases of acute bacillary dysentery within three or four days from the onset of the disease, yet it is usual not to obtain agglutination with the patient’s serum before the tenth day. With the Shiga strains agglutinating power in 1 to 50 is usually accepted as evidence of specificity but for Flexner strains we generally have a higher titre so that a dilution of 1 to 150 should be required for the test.
Ritchie has recently tested the sera of 792 normal persons and found that 30% of these individuals agglutinated Shiga bacilli in 1 to 32, while with Flexner strains 41% agglutinated in 1 to 64 and 30% in 1 to 128. For comparison Ritchie’s results with typhoid showed that only 6% agglutinated such bacilli in 1 to 16. There is some evidence that typhoid vaccination increases the agglutinating power of the serum against dysentery organisms. These findings are remarkable, as the usual advice is to consider an agglutination of 1 to 30 as fairly specific for Shiga infections and 1 to 100 for Flexner ones.
Willmore and Savage tried heating serum to 56°C. for thirty minutes, but found that such a procedure was of no practical value with dysentery, thus differing from Malta fever serum where such a procedure is of value in destroying coagglutinins and thus increasing the specific action. The work of Ohno would indicate that we should trust to the acid-producing effect on mannite for differentiating Flexner and Shiga strains rather than on agglutination because it was found that agglutinins for an acid strain were not always more specific for such strains than for nonacid ones.
At the same time it is the rule for a Flexner type bacillus to show specificity for its serum and the Shiga type for the serum of the more toxic, nonacid-fast Shiga strain cases. The statement of Willmore and Savage that the differentiation of bacillary dysentery infections is a refinement of technique seems a proper view because with a polyvalent serum for treatment one only needs to know that the case is one of bacillary dysentery for proper treatment. Of course with a monovalent serum, effective only for the Shiga bacillus, one would have to determine whether the organism producing the dysentery was of that strain.
As a matter of fact it takes considerable time and laboratory skill to carry out reliable cultural and serological tests.
From a practical standpoint we can use the therapeutic polyvalent serum for agglutination and any organism recovered on the plate made from the faeces which agglutinates in 1 to 50 or 1 to 100 may be considered as diagnostic of bacillary as against amoebic dysentery. Often one does not see a case of dysentery until late in the disease and then, provided the condition is serious and the diagnosis points to a bacillary infection it would be better to inject the curative serum rather than await laboratory confirmation.
Prophylaxis and Treatment
Prophylaxis.—The ease with which water-closet seats may be contaminated should make us pay great attention to their disinfection during an outbreak of bacillary dysentery. The same applies to the bedclothes of such patients sent out for laundering.
Great care should be given to the washing of one’s hands prior to eating. The greatest care must be taken with rectal tubes when used for treatment. It is better to make an invariable rule to confine the use of a single tube to a single patient, as the rubber tubes are difficult to disinfect other than by boiling and such treatment, especially in the tropics, soon ruins the tube. For disinfecting tubes a 5% solution of liquor cresolis compositus is good. The tubes should be thoroughly washed of the disinfectant before using again. For disinfection of faeces one can use an equal portion of the above disinfectant to a similar amount of stool leaving the disinfectant to act on the stool at least one hour before emptying the receptacle. Soiled clothes should be disinfected in a 2½% solution of the compound cresol solution. Flies must be kept in mind and water and milk supplies boiled. The carrier is of as great importance here as in typhoid or cholera, especially when assisting in preparing food.
Vaccination.—Vaccination against dysentery does not seem to have made much headway owing to the very severe reactions following injections of killed cultures of the Shiga bacillus. By injecting such bacilli treated with an immune serum (sensitized) the reaction is less severe.
Dean reports the value of treating the emulsion of organisms with an equal amount of 1 to 1000 eusol. Gibson treated a suspension of dead organisms with an equal amount of serum, mixing in the syringe at the time of injection. Although this method was used during the war its immunizing value was not settled.
The question of the best method of preparing vaccines for prophylactic use is still unsettled. The greatest difficulty has been experienced in making vaccines of the Shiga bacillus on account of the great toxicity of such preparations.
The serum alone is used almost exclusively for curative rather than prophylactic purposes.
Treatment.—In the treatment of bacillary dysentery absolute rest in bed is important to keep up the strength of the patient and also to protect the heart which tends to be more or less damaged by the toxic action of the Shiga bacillus. Some prefer to prop up the patient in bed, considering a strict dorsal decubitus as undesirable. It is important to use sufficient covering on the patient to avoid chilling. A light wool blanket spread over the abdomen is often all that is needed in the tropics.
Some authorities deal with the subject of treatment without referring to any other means than the administration of serum. This probably is the proper attitude when the very fatal Shiga type infections are encountered. It must be remembered that certain epidemics, which as a rule are associated with the Shiga type bacillus, give a very high mortality (20 to 40%) while other epidemics seem associated with a less virulent strain of this bacillus.
At any rate when a case is seen early it would seem advisable to give about 2 grains of calomel in divided doses of ¼ grain every half hour and then follow it up with saline treatment. Most authorities recommend a preliminary dose of castor oil. During the first day or two enemata of normal saline, boric acid or 1½% sodium bicarbonate solution in 2 pint amounts would seem indicated as assisting the salines in the elimination of toxic material. After that time the tenesmus and rectal irritation make the use of the rectal tube too trying to the patient. I have used the Murphy protoclysis method with a certain degree of success, but this procedure cannot be kept up long. Hot fomentations to the belly relieve the griping pains.
The saline treatment is highly recommended by Buchanan who gives 60 grains of sodium sulphate every two or three hours until the dysenteric character of the stool disappears.
Bahr in the Fiji islands treated 53 consecutive cases, of which 41% had marked constitutional symptoms, with a mortality of 13.2%. He gave 1 dram of sodium sulphate every hour for the first day and subsequently the same dose every four hours.
In a second series of 106 cases, of which 42% had marked constitutional symptoms, he treated 34 with salines plus the administration of capsules of cyllin. The remaining 72 cases received in addition to this treatment injections of a polyvalent serum obtained from the Lister Institute. The mortality in this series was 1.8%. He notes that 5 of the cases in this second series were of the severest type as evidenced by the gangrenous stools and toxic condition and yet not one of these five serum-treated cases died. He notes that the stools of those who received serum injections became normal in five days for an average while for those treated with saline alone the average period was eight days.
Bahr strongly recommends the combined treatment of salines and serum. In very severe cases Bahr used 50 to 70 cc. of the serum but ordinarily 20 cc. for adults and 10 cc. or less for children.
Willmore and Savage think one obtains the best results by injecting from 80 to 120 cc. of a polyvalent serum into the subcutaneous tissues of the flank or abdomen or intravenously. They think that anaphylaxis is less liable to follow a massive initial dose of serum.
In the use of serum Shiga recommends a dose of 10 cc. for a mild case or two injections of 10 cc. at intervals of ten hours for cases of medium severity, while in very toxic cases he uses 60 cc. in 3 daily doses of 20 cc. each. It is important to use serum early as it has little or no effect if used after the 7th day (Klein).
The best known sera are those of Shiga, Dopter and that prepared by the Lister Institute.
Animal charcoal and bolus alba are considered of value by some physicians. Opium should be avoided. Intravenous saline injections are of value in cases showing collapse signs. Again, such cases, from the standpoint of possible adrenal insufficiency, may be helped by adrenalin. Where there is a very small rapid pulse with marked cardiac weakness injections of camphor in oil may be of value.
Subcutaneous injections of ordinary or hypertonic saline containing about 10 drops of 1 to 1000 adrenalin solution is of value in collapse.
Ross considers opium as of value in dysentery and states that he regards ipecac as of value not only in amoebic but in bacillary dysentery as well. I have often given salol-coated pills containing 1 grain of ipecac and ⅙ grain of calomel every two hours to cases of bacillary dysentery with apparent benefit.
For the diet of cases of acute bacillary dysentery albumin water or barley water sweetened with lactose is to be preferred to milk, which is usually not well borne by such patients. Kendall has noted the value of sugar of milk in lessening the toxicity of various organisms. Tea sweetened with lactose is usually well borne. Meat juice expressed from a piece of lightly broiled steak is good. Various jellies or sago pudding are of value. Willmore and Savage praise yoghurt.
Unless given in small amounts liquid diet is apt to increase evacuations and some cases seem to do better on ordinary diet.
In the tropics there are many brands of sterilized natural milk and these can be inoculated with a culture of B. bulgaricus.
In chronic bacillary dysentery Rogers recommends 1 to 1½ pint enemata of albargin in strength of 1 to 500. Protargol seems to be equally efficient in the same strength. Owing to the effect of organic material on silver nitrate this salt does not seem so reliable as the organic silver compounds. It has also been recommended to flush the colon with warm boric acid solution. Another recommendation is to use milk for this purpose. Vaccine treatment has been employed, in cases of chronic bacillary dysentery. Either eusol-treated organisms or those sterilized by 0.25% trikresol are to be preferred.
CHAPTER XIII
PLAGUE
Definition and Synonyms
Definition.—Plague is primarily a disease of rats or other rodents and is caused by a bacterium of the haemorrhagic septicaemia group, Bacillus pestis. The disease exists in the rodent in both an acute and chronic form. Acute plague of the rat is apt to be septicaemic, so that when certain species of fleas which infest the rat feed on the blood of their host they ingest plague bacilli. These seem to multiply in the region of the proventriculus and cause thereby an obstruction to the stomach. As a result the flea makes vigorous and repeated but ineffectual efforts to feed. Regurgitation of the contents of the oesophagus occurs, thereby inoculating plague bacilli. When the rats die these fleas will attack man and cause human plague. The ordinary type in man is bubonic plague, characterized by extremely tender glandular enlargements. This form of the disease is thought to be exclusively transmitted from man to man by fleas or possibly bedbugs. A second type is pneumonic plague which is a surely fatal pneumonia which is transmitted from man to man by droplets of sputum expelled in coughing. Either the bubonic or pneumonic types may become septicaemic or this form may exist from the start.
Plague shows a marked clouding of the consciousness from the onset and is characterized by toxic action on the heart and endothelial lining of capillaries.
Synonyms.—Oriental Plague, Black Death, Pestis. French: La Peste. German: Die Peste.
History and Geographical Distribution
History.—Ancient writers were accustomed to apply the designation “plague” to any disease which was epidemic in character and attended with great mortality. This explains why the plague of Athens and that of Marcus Aurelius, which epidemics did not possess the characteristics of oriental plague, were so designated. There exist however writings which show that fatal epidemic diseases attended with buboes and prostration were noted prior to the Christian era.
It is probable that the biblical description of a disease among the Philistines which was attended with buboes and killed the mice of the field referred to plague.
In the 6th century, during the reign of Justinian, a disease which was unmistakably plague started from Egypt and reaching Constantinople caused the death of 10,000 persons in one day. It spread throughout the entire Roman empire.
The “Black Death.”—The most noted epidemic of plague was that of the “Black Death” of the 14th century. The disease seems to have originated in the East, possibly in China, and eventually invaded Asia Minor, Egypt and Europe. The disease was called “Black Death” in Germany, on account of the petechial spots or “tokens” and in Italy, the “Great Mortality.”
In the records of the epidemic we note that it was attended with great stupefaction, the sick losing their speech from palsy of the tongue. Others noted buboes of groins and arms while some noted a putrid inflammation of the lungs with the expectoration of blood. In the plague at Avignon it was noted that at first, for six or eight weeks, the sick expectorated blood and that to come near them was certain death. Afterwards buboes appeared in groin and axilla and some of the sick recovered.
Quarantine.—It was during this epidemic that quarantine became a recognized procedure in Europe. The adoption of a period of detention of forty days probably originated in the medical idea that the 40th day was the last day of ardent diseases, this being one of the critical days. The lazarettos, where strangers were held in quarantine, appear to have first been established on some island near Venice, in 1485.
It has been estimated that one-fourth of the population of Europe succumbed to the “Black Death,” but estimates in certain parts of Europe would indicate a mortality approaching 70% of the inhabitants.
In 1665 occurred the Great Plague of London, during which year it was estimated that approximately 60,000 out of a population of 450,000 died. It was thought that this epidemic was introduced from the Levant by way of Holland.
There was much plague in Europe in the 18th century but it would seem to have completely disappeared by 1841 and only to have returned with the present pandemic.
The Present Pandemic.—The plague epidemic with which all parts of the world are now so concerned is supposed to have originated in China, in the province of Yunnan, and from that center to have reached Canton, in 1894, causing the death of 60,000 people in a population of 1,500,000. In the same year it extended to Hong Kong and from that great seaport has spread over the entire world. India has suffered more than any other country, there having been years when the plague deaths exceeded 1,000,000.
In a recent article by Low it is noted that the highest death rate was reached in 1907 when 1,315,892 persons died. From the time of the introduction of plague into India to the end of 1917 there were 9,841,396 deaths from this disease.
In its spread it has invaded Europe, Egypt, South Africa, Australia, Japan, Philippine Islands, California and parts of Central and South America. It has recently made its appearance in New Orleans.
Geographical Distribution.—At present there are only two important foci of endemicity, one Mesopotamia and another in the region of the Himalayas (India, Thibet and Yunnan). There also seem to be less important centers in Uganda, in Africa, and in the trans-Baikal region of Siberia. In view of the rather widespread[190] infection of the California ground squirrels, from which rodents the disease has from time to time spread to man, it would seem probable that California might be considered another focus of plague.
Etiology and Epidemiology
Etiology.—The bacillus of plague was first isolated by Yersin from a plague bubo, in 1894, at Hong Kong. It is true that Kitasato reported a bacillus which he had isolated from the blood of a plague patient, on July 7, 1894 (Yersin’s report was made July 30, 1894). Kitasato’s bacillus was motile, Gram-positive, coagulated milk and gave a turbidity in bouillon, characteristics which were just the opposite of those of the organism reported by Yersin.

As now recognized the plague bacillus, when in smears from pathological material, shows the form of an oval bacillus, the ends of which stain more intensely than the central portion (bipolar staining). When cultured on ordinary agar, the morphology is more rod-shaped with a tendency to pleomorphism.
These agar cultures are very sticky and mucilaginous. If 3% of NaCl is added to the agar, this pleomorphism is exaggerated, there occurring coccoid, root-shaped and various bizarre involution forms.
For obtaining the involution-form appearance on 3% salt agar one should transfer liberally from the ordinary agar growth to the salt agar rather than planting direct from the pathological material.
A bouillon culture, upon the surface of which there has been deposited drops of oil or melted butter, shows a string-like downward growth from the under surface of the oil globules. This “stalactite” growth is very fragile and is difficult to obtain.
Ordinary bouillon cultures show a rather powdery deposit at the bottom and a hanging-drop preparation from such a culture shows chains of plague organisms resembling streptococci. Gelatine is not liquefied. Bacillus pestis grows readily at room temperature as well as at 37°C, and one may be struck with the fact that colonies on agar plates may show variations in degree of development so that the suspicion of a contaminated culture may arise. Human plague material for cultures or smears is best obtained from the bubo prior to suppuration in bubonic plague, from the blood in septicaemic plague and from the watery sputum in pneumonic plague.
Plague in the Rat.—With acute plague in the rat one finds marked injection of the subcuticular surface of an exposed abdominal flap; certain glands, especially the neck ones, show marked congestion, haemorrhagic necrosis and periglandular infiltration; the pleural cavity contains much fluid; the liver has a yellow mottled appearance liberally sprinkled with discrete, yellowish-white granules about the size of a pin’s head, while the spleen is enlarged. Smears from the spleen or affected glands, as a rule, show the bacilli in great numbers. The San Francisco findings in plague rat autopsies varied somewhat from those noted above, which held for Indian plague rats.
Confusing Organisms.—Other organisms which may be obtained from plague-suspected material are those of the proteus or colon group, which may show bipolar staining, but culturally are quite different. Klein has noted that a nonmotile rod, which gives a striking bipolar staining and named Bacillus bristolensis, may be mistaken for the plague bacillus. Its growth in bouillon is similar to that of B. coli and it coagulates milk.
An organism, B. pseudotuberculosis rodentium, resembles the plague bacillus in a striking manner but is without virulence for rats. It is virulent however for guinea pigs and these animals can be immunized against plague with this closely related organism. Litmus milk cultures of plague show a very slight acidity while with B. pseudotuberculosis rodentium there is a high degree of alkalinity produced.
Wherry has reported two cases of ulcerative conjunctivitis with lymphadenitis of cervical glands, fever and marked prostration, due to infection with B. tularense, occurring in persons who had handled rabbits which had died of this plague-like infection. The organism was first noted by McCoy in squirrels in California. The symptoms and lesions in these animals are those of plague. Guinea pigs succumb after the cutaneous inoculation of material and show lesions markedly resembling plague. The organism, however, will not grow on ordinary simple media as does the plague bacillus. As will be noted in the chapter on Tularaemia the disease has a very limited geographical distribution.
The crucial test for any plague material is the power of the plague bacillus to infect a rat or guinea pig, when the material is rubbed on the shaven skin of the animal. B. tularense will also pass through intact[192] shaven skin and it produces lesions in the guinea pig similar to those of plague. Other organisms, however which might infect through intact skin produce lesions unlike those of plague. As a practical point it may be stated that cases showing a profusion of oval, bipolarly staining bacilli, in smears from glands or sputum, and with clinical manifestations of plague, are not likely to be other than plague; still, to be conservative, one should always inoculate animals cutaneously or subcutaneously.

Epidemiology.—Plague is primarily a disease of rodents, usually rats, and man contracts his infection from these animals. With the exception of pneumonic plague which, under certain circumstances, is transmitted directly from man to man, plague infections originate from the bite of fleas which have become infected from feeding on the blood of plague rats. Infected fleas act as intermediaries in plague epizootics among rats. It is true that a rat might become infected from bites received in a fight with an infected rat, or man might be infected through a cut on a finger while handling plague material, but such methods play but a small part in plague epidemiology.
Fleas and Plague.—In 1897, Ogata infected mice by inoculating them with an emulsion of crushed fleas taken from plague rats. In 1898 Simond showed that if a rat, dead of plague, were placed in a large bottle and a healthy rat confined in a small cage introduced into the bottle and suspended above the dead rat, so that there could be no contact between the dead and the living animal, the well rat would contract the disease. If however the fleas were removed from the dead rat, before the introduction of the caged rat, no infection took place.
By reason of claims that the rat flea would not bite man these convincing experiments were in a measure disregarded. The complete confirmation of the correctness of this view, as to transmission of bubonic plague, was brought about by the Indian Plague Commission. In a large number of experiments it was shown that when healthy and plague-infected guinea pigs were confined together in spaces where there were no fleas, there were no plague infections of any of these well animals.

Fig. 65.—1 and 2, male and female Xenopsylla cheopis. 3, Head of Ceratophyllus. 4 and 5, male and egg-distended female of Sarcopsylla penetrans.
Xenopsylla cheopis is the most important plague transmitter of the flea family as it is the common rat flea of India where there is so much plague.
Sarcopsylla or Dermatophilus penetrans is an important factor in a disabling skin disease, especially of the feet, in many parts of the tropics.
On the other hand in 35 experiments, when fleas had access to the spaces, plague infections were the rule. Again, guinea pigs in cages which were suspended only two inches above a plague flea infected floor, became infected, but other animals, which were suspended so high that the fleas could not jump up to them, remained well. Two cages, each containing a monkey, were placed in a plague flea infected room. One was surrounded with a protecting zone of 6 inches of “tanglefoot” fly paper, this being the limit of the distance a flea can jump, while the other cage was not so protected. The monkey in the cage without the sticky paper contracted plague while the second monkey remained well. It is only when there is a great incidence of plague among rats that we have outbreaks of bubonic plague in man, and it has been noted that the greater the epizootic, the more heavily infected was the blood of the sick rats with the plague bacilli. A flea with a stomach capacity of about ½ c.mm. could take in several thousand plague bacilli in a feeding on a rat whose blood was teeming with bacilli. The blood of a rat dying with plague may contain as many as fifty million bacilli to the cc. Human blood rarely contains more than a million to the cc. There is a multiplication of the organisms in the flea, so that when it defecates, thousands of plague bacilli are deposited near the puncture wound made by the flea when subsequently feeding on a man. The infected faeces are rubbed into the wound by the man in scratching the site of the bite, so that we have here an instance of a contaminative method of infection as contrasted with the inoculative method by the mosquito in malaria.

Fig. 66.—1, Ctenocephalus felis. 2, Ceratophyllus fasciatus. 3, Hoplopsyllus anomalus. 4, Ctenopsylla musculi. 5, Xenopsylla cheopis. 6, Pulex irritans. 7, Internal anatomy of flea. (After Fox.) (a) Maxillary palpus; (a-1) epipharynx; (a-2) mandible; (a-3) labial palpi; (a-4) maxillae; (a-5) basal elements of rostrum and mandibles; (b) salivary pump; (c) hypopharynx; (d) aspiratory pharynx; (e) muscles of the aspiratory pharynx; (f) eye; (g) oesophageal ganglia (brain); (h) thoracic ganglia; (i) oesophagus; (j) salivary duct; (k) gizzard; (l) salivary gland; (m) stomach; (n) aorta; (o) ovaries; (p) malpighian tubules; (q) pygidium; (r) rectum showing rectal glands; (s) anus; (t) intestines; (u) bursa copulatrix; (u-1) ductus obturatorius (blind duct); (v) receptaculi seminis or spermatheca; (w) ducts of spermatheca; (x) vagina; (y) uterus; (z) abdominal ganglia.
Bacot and Martin have shown that while infection may take place as the result of the faeces being rubbed into the wound made at the time of feeding yet the ordinary way is probably by regurgitation from the oesophagus of the flea at the time of feeding.
Upon taking in plague septicaemia blood the bacilli multiply about the site of the proventriculus as well as distending the oesophagus. This makes an obstruction to the entrance of the stomach resulting in starvation of the flea. This naturally makes the flea more voracious and in the ineffectual muscular efforts to take in blood, regurgitation of the contents of the oesophagus occurs, thereby infecting the person upon whom the flea is trying to feed. This obstruction apparently may be overcome in some way as the plague-infected flea does not necessarily die. Still from lack of sufficient fluid such fleas are liable to be killed off if the relative humidity is low, as in dry weather. Further investigations have shown that the proventricular plug may be channeled, but in such case valve action is lost and the contents of the stomach are regurgitated, thus making such a flea more dangerous than one with an obstructed proventriculus. Such fleas may continue infectious for 67 days.
Very interesting in this connection is the fact that Heiser found plague-infected fleas in the desk of a European at Manila who died of plague. A mummified rat was found in one of the drawers of this desk, from which successful animal inoculations for plague were made. Heiser notes that data would indicate that these fleas probably remained alive 2 weeks after the death of the rat which brought about their infection. Another very striking finding during the same Manila plague outbreak (1912-1913) was that bedbugs found on the sleeping mat of a human victim of plague showed bipolarly staining bacilli.
Bacot has carried on experiments in which fleas infected two months previously and kept in a cool place could transmit plague. This would indicate the danger from plague-infected fleas which had been held in material packed away in boxes.
Method of Spread.—The spread of plague epizootics among rats seems to be rather by the fierce brown sewer rat, Mus norvegicus. The more delicate black house rat, Mus rattus, usually receives its infection from the sewer rat. When the rat dies the fleas leave the dead body and seek a new host, preferably one similar to the one just abandoned. The sewer rat reaching the basement of houses and dying of plague is deserted by his fleas. These will attach themselves to the house rats which go from basement to roof of the house and later these dying are[196] abandoned by the fleas which, in the absence of a rodent host, will feed on man and infect him.
The house rat is rarely found in Europe while in many parts of the tropics it is common and in close association with man. The fact that the sewer rat avoids the upper portions of houses probably explains the greater infrequency of plague epidemics in Europe where this rodent is common. In former ages when the house rat was prevalent in Europe we had great epidemics there. Mus (Rattus) norvegicus is of stout build with a blunt nose and small opaque ears which barely reach the eyes when laid forward. The tail is shorter than the length of the head and body together (89% of such length). With Mus rattus we have a delicately built rat with a slender head and sharp nose. The ears are translucent and large and reach beyond the middle of the eye when extended. The rather delicate tail is about 25% longer than the length of the head and body taken together.
Recently it has been found that a guinea pig set free in a house suspected of having plague fleas becomes infected if such fleas are present. The fleas would probably prefer the guinea pig to man and such a measure would in some degree be protective to man. It is however for the detection of plague infection that the measure is employed and the guinea pig is termed the “Plague barometer.” In Madras there is practically an absence of Mus norvegicus although Mus rattus is present in numbers and the comparative freedom of the city from plague is striking.
The principal rat flea of the Orient is Xenopsylla cheopis. This flea is without combs like Pulex irritans, the human flea, but is of a lighter color and has an ocular bristle near the upper margin of eye and two bristles posterior to the antennae. In Europe and the United States Ceratophyllus fasciatus is the common rat flea. Many other species of fleas transmit plague and it is also possible that the bedbug may play a part in spreading infections from man to man. Vergbitski has transmitted plague from man to the rat by infected bedbugs. In Siberia, a marmot, the tarabagan, is supposed to play the part of the rat in plague transmission. In California, the ground squirrel, Citellus beecheyi, has become infected and may transmit the disease by its flea, Ceratophyllus acutus. In the Tropics plague tends to prevail only at times when the temperature is between 10° and 30°C. It is the effect on the flea of cold weather which causes the disappearance of bubonic plague at such times. The bacillus of plague can withstand freezing temperatures. Sunlight and drying are the especially inimical factors for B. pestis. Dry seasons are inimical to the spread of plague and it is especially in very rainy seasons that epidemics rage.
Chronic Plague in Rats.—The Indian investigators have called attention to the existence of a chronic plague in rats. In this we have chronic buboes, areas of necrosis in spleen and abscesses of the spleen. It is chiefly in the spleen that the lesions occur, thus differing from the acute plague in rats above described. Of 27,699 M. norvegicus, examined in Bombay, O.57% showed signs of chronic plague.
In the necrotic material plague bacilli can be found in approximately one-half of these rats although frequently the bacilli are nonvirulent. It is possible that[197] this chronic plague in rats may serve as the reservoir of infection which keeps up plague epizootics from year to year. Plague in India, according to White is less virulent now than formerly and this is attributed to a greater immunity of the rats.
As regards pneumonic plague the origin of such epidemics is probably from pneumonia occurring secondarily in cases of bubonic plague. Provided the conditions are favorable, particularly as to moisture in the air of the room, the infection spreads directly from man to man as a result of the droplets of heavily infected sputum being sprayed into the air in the act of coughing on the part of the patient. It is an instance of Flügge’s droplet method of infection.
In the recent epidemic of pneumonic plague in North China, it was at first thought that the hunting of the tarabagan for its valuable skin, which led some of the Chinese to even capture tarabagans, possibly sick with plague, was the origin of the epidemic. This view is no longer held and we now know that the outbreak was independent of any disease in rats, tarabagans or other animals. Strong has shown that the bacillus which was isolated from these cases of pneumonic plague was identical with that isolated from cases of bubonic plague; its virulence was no greater and animals infected cutaneously or subcutaneously died of bubonic plague. Experiments by Teague and Barber, with emulsions of plague bacilli, showed that with a room temperature of 32°C. plague bacilli were quickly destroyed when the air was comparatively dry. In such an atmosphere, saturated with moisture, the viability would be greatly prolonged. In the plague wards in Manchuria the extreme cold which prevailed, together with the saturation of the atmosphere of the unventilated rooms by the moisture of the breath of the patients, made conditions most favorable for the viability of the plague bacillus. They note that in the plains of India, although about 3% of bubonic cases assume a pneumonic type, yet epidemics of plague pneumonia do not occur; this is probably due to the fact that the higher temperatures and open rooms make evaporation occur 30 times more rapidly there than was the case in the plague wards in the bitter cold weather of the Manchurian winter. The possibility of carriers of plague bacilli in those who might go on to convalescence need not be considered, as practically all cases of plague pneumonia die. Other material from the patient than sputum does not seem to be a source of danger in the spread of plague, so that there is no need for the disinfection of urine and feces. There has recently been an outbreak of septicaemic plague in Ceylon in which there was an absence of plague in the rats. The infection was possibly transferred directly through bedbugs or human fleas. As a matter of experience the transference of plague from place to place generally occurs from infected rats or infected fleas which have been transported by ships. A case of bubonic plague in a ward with other patients would not be a source of danger provided there was freedom from fleas and a lack of development of secondary pneumonias. It is very doubtful as to infection ever taking place by way of the alimentary canal, although there is some evidence that rarely the tonsil may be primarily involved. Monkeys are very susceptible to plague and the possibility of an epizootic among them should be thought of during plague epidemics.
Pathology
It is rare that one finds the primary vesicle marking the site of entrance of the plague material. Thus in 13 cases where plague was contracted by direct cutaneous inoculation of those performing autopsies on plague victims only two showed evidences of local reaction as shown by the formation of a primary vesicle.
The chief points noted in a plague autopsy are: (1) The marked involvement of the lymphatic system as shown by intense congestion and haemorrhagic oedema of the lymphatic glands. Not only are the glands tributary to the site of inoculation involved, thus forming the primary bubo, but there is secondarily more or less inflammatory change in all the lymphatic glands of the body. There is also a marked periglandular oedema, with haemorrhagic extravasations of the connective tissue surrounding the primary bubo, this mass being made up of a group of glands matted together by this periglandular exudate.
(2) The destructive effect of a toxic product of the plague bacillus, which may be designated an endotheliolysin, upon the endothelial cell lining of blood vessels as well as lymphatic ones. This causes the extensive blood extravasations so characteristic of plague as shown by petechial spots, not only of the skin but of the serous and mucous membranes as well.
There is a general congestion of all organs of the body.
The meninges of the brain are deeply congested and there may be haemorrhagic extravasations in the brain substance itself. Crowell has reported two cases of plague meningitis in which plague bacilli were found in the ventricular pus. The spleen is generally markedly congested and enlarged to 2 or 3 times its normal size.
There may be haemorrhagic extravasations throughout the spleen pulp. The bacilli are chiefly scattered throughout the venous sinuses.
There is also active congestion of the liver. The kidneys are intensely congested and we often find fibrin thrombi in the tufts of the Malpighian bodies.
The plague toxin has a marked effect on the cardiac muscle so that we usually find dilatation of the right side of the heart with fatty degeneration of the muscle fibers.
In a study of the pathology of primary pneumonic plague Strong noted pericardial and pleural ecchymoses with fibrinous pleurisy over the affected lung areas.
The process was at first lobular but later involved the entire lobe.
There was marked congestion of the bronchial mucosa with involvement of the bronchial glands. The larynx and trachea are also intensely congested. Microscopically there is a distension of the alveoli and bronchial passages with a haemorrhagic exudate. There is practically no fibrin in the alveolar exudate. The process seems to extend by continuity along the bronchi and bronchioles.
Plague bacilli pack the exudate found in the bronchi and bronchioles.
In a report on the autopsy findings of septicaemic plague in Ceylon in cases[199] where plague bacilli were demonstrated in smears and cultures from spleen and blood, Castellani noted that other than meningeal congestion and some splenic enlargement there was nothing abnormal.
Symptomatology
In a clinical study of plague it is customary to consider the disease as manifesting itself in a mild form (Pestis minor) and a severe form (Pestis major).
Pestis Minor.—Pestis minor, which is sometimes termed pestis ambulans, is that form of plague in which there is only slight fever and comparatively little physical prostration or mental hebetude. These cases usually show moderate enlargement and tenderness of some group of lymphatic glands. It is in this mild form of plague that we are most apt to find the primary vesicle or phlyctenule at the site of the flea bite.
Ordinarily, man is so susceptible to plague that there is no reaction at the site of inoculation but in these mild cases there is an inflammatory reaction resulting in a vesicle or pustule, which may teem with plague bacilli. In such cases it is extremely important to search for such primary vesicles and examine for plague bacilli. It is usually stated that only about 5% of cases of bubonic plague show these vesicles.
Pestis Major.—Pestis major can certainly be divided clinically and epidemiologically into two types, pestis bubonica, or bubonic plague, which is the common type of plague, and pestis pneumonica, or pneumonic plague, the contagiousness of which is extreme and the mortality practically 100%.
Both of these types of plague tend finally to show an invasion of the blood stream with plague bacilli, the case then becoming one of septicaemic plague. Many authors, however, recognize an overwhelming plague septicaemia in which the manifestations of buboes or pneumonia are absent and such cases are designated septicaemic plague, or pestis siderans.
In all forms of pestis major there stand out the characteristics of rather sudden onset, rigors or chilly sensations, rapidly rising but irregular fever, marked giddiness, great prostration, the mental state and speech of an intoxicated person and extreme weakness of the heart with a rapid weak pulse.
Typhus fever alone shows an equal degree of early mental hebetude, so that it is stated that Clot Bey, who had seen much plague in Egypt, when elsewhere shown cases of typhus with parotid involvement, remarked “In Egypt one would call such cases plague.”
A Typical Case of Bubonic Plague.—After a period of incubation of from three to seven days the disease may set in quite abruptly, or after[200] a prodromal stage, in which malaise, giddiness, mental hebetude and pains in the back and limbs may be present. With the onset of the attack the effects of the toxaemia upon the nervous system are the most striking. The patient has a pale, drawn, anxious countenance, with injection of the conjunctivae toward the inner canthus.
The speech is thick and difficult, the gait is staggering, so that, with the stupid mental state and tendency to wander aimlessly about, one has the symptom-complex of an alcoholic intoxication. In some cases a delirious tendency may be marked, especially as the disease develops. After a few hours, or within a day, the fever begins to rise rapidly and is often associated with shivering attacks. The face now becomes hot and flushed, the conjunctivae markedly injected, the pupils dilated, and the eyes rather staring. The temperature is as a rule from 102° to 104°F., occasionally higher, with a tendency to rather marked remissions and, on the whole, of great irregularity of the fever curve. The pulse is rapid and shows early indications of the extreme toxic effect exercised upon the heart. Cardiac weakness is a marked feature of plague.
The urinary secretion is diminished but there is rarely more than a slight amount of albumin.
The Pathognomonic Bubo.—About the second or third day the development of an extremely painful bubo practically gives the diagnosis.
About 70% of these buboes are of the inguinal region, the femoral glands being more frequently invaded than those above Poupart’s ligament. The axillary glands are involved in about 20% and the submaxillary and cervical ones in from 5 to 10% of cases.
There is a question whether the tonsil ever serves as the site of infection from which cervical buboes result. It would seem that the greater frequency of inguinal buboes is because a greater area of skin drains into these glands. There may be multiple buboes and it must not be forgotten that the lymphatic glands of any region may become enlarged. There may also be lymphangitis. Only one gland of a group may be involved or the whole group may show enlargement. Very characteristic for plague buboes is the oedema of the periglandular tissues, which is largely responsible for the great size of some of these buboes; they may vary from the size of an almond or walnut to that of a child’s head. The patient tends to assume an attitude to relieve any tension on the very painful bubo. Particularly over these buboes, but at times elsewhere, the skin may show areas of inflammation, often several inches in diameter. Necrosis of this area occurs and a slough separates. These lesions are often termed carbuncles but are really not such, but only gangrenous patches of skin.
When these areas of cutaneous necrosis are a marked feature the designation of cellulo-cutaneous plague is at times given.
Petechiae or large purpuric spots may be conspicuous in some epidemics and it was from these “tokens,” as they were called, that plague received the designation “black death.”
As the case progresses, the anxious countenance gives way to one of apathy, the control of speech and cerebration become more and more impaired and the patient may go into a typhoid state.
Cases with buboes in the axillae give the gravest prognosis, as for example, 80% mortality for axillary, and 70% for inguinal. The buboes may suppurate towards the end of a week or they may undergo a slow resolution. Secondary broncho-pneumonia may develop in the course of bubonic plague. Pulmonary congestion is however not infrequent and may cause dyspnoea, accelerated respiration and cough. Owing to the tendency to degeneration of the endothelial lining of capillaries, various haemorrhagic manifestations, other than those of the skin, may be observed, such as epistaxis, haematuria, etc. There is usually a rather marked leucocytosis in which the increase is chiefly of the polymorphonuclears.

Fig. 67.—A, Temperature chart of fatal case of bubonic plague. B, Chart of case of bubonic plague going on to recovery but with suppuration of plague bubo. C, Chart of fatal case of pneumonic plague.
A Typical Case of Pneumonic Plague.—Besides those cases where pulmonary involvement sets in during the course of an attack of bubonic plague and which are classified as secondary plague pneumonias we have sporadic cases and epidemics when the clinical course of the disease is predominantly and primarily pulmonary.
Although the characteristics of pulmonary involvement, with expectoration of blood, were noted by many observers of the 14th century and later as manifestations of plague, yet in the present pandemic, which started in 1894, such cases were at first overlooked as being plague. The recognition of a primary pneumonic plague was made by Childe in 1897. The onset is sudden, with a rise of temperature to 103°F., or higher, during the first day. The marked physical exhaustion and clouding of the consciousness, characteristic of any type of pestis major, are intensified[202] in pneumonic plague. In fact the occurrence of manifestations of such profound toxaemia in the presence of only slight physical signs, should make one suspicious. Crepitation over small areas, without demonstrable dulness on percussion, may be the only sign. There is often early dyspnoea and rapid shallow respiration. Cough, with the expectoration of rather abundant watery sputum, which soon becomes blood-stained or absolutely sanguineous, may be present by the second day.

There is never the rusty, tenacious sputum of lobar pneumonia. Herpes never appears, according to Childe. Heart failure is a very prominent feature of plague pneumonia.
It is fortunate that this watery sputum teems with bacilli early in the disease as smears from such sputum give an early and sure diagnosis of this terribly contagious and fatal malady. The knowledge that this infection is transmitted from man to man by the droplets of sputum expelled in coughing demands the protection by some form of mask of anyone coming near such a patient. Some observers noted splenic enlargement and tenderness over the superficial lymphatic glands.[203] Strong has noted that the course of the disease rarely extends beyond the fourth day and that death is the invariable termination.
In 1919 thirteen cases of plague pneumonia occurred in California starting from an at first unrecognized case of bubonic plague of squirrel origin. These pneumonias were diagnosed as influenza pneumonias but later the true diagnosis was determined. McCoy notes in this connection that there is a strong tendency to pulmonary localization of plague in the squirrel which is not true of the rat.
Septicaemic Plague.—As regards the clinical manifestations of septicaemic plague, if such be considered as a separate type, Choksy states that there is no clinical sign by which such a septicaemia can be recognized without the help of the laboratory, although the presence of a thready or imperceptible pulse, in one showing the characteristic toxaemia of plague, should cause suspicion.
The patient may be so overwhelmed from the start that there may be only a slight rise of temperature. Occasionally, plague bacilli may be recognized in blood smears, a finding that practically never obtains in any other bacterial disease. At the same time blood cultures are solely to be depended upon in diagnosis and even such examinations may be negative. Liston has noted that plague patients always die if more than 40 bacilli per cc. are present in the blood. In a recent outbreak of septicaemic plague in Ceylon the only clinical manifestations were intense headache, and fever. The patients died within forty-eight hours. Until properly diagnosed bacteriologically the disease was thought to be pernicious malaria.
The Symptoms in Detail
General Appearance.—The face is at first drawn and pallid, the eyes injected and the expression one of fear or anxiety. As the temperature rises the pallor is succeeded by a flushed and dry hot skin. Later on in the disease the expression is more one of apathy. The staggering gait and the tendency to wander give the impression of alcoholic intoxication.
Temperature Curve.—The fever course of plague is very irregular. The temperature usually rises rapidly to 103° to 104°F., but tends to exhibit marked remissions by the third day. After a fall, it may rise to a very high degree just before death. Cases which recover often show a fall by lysis.
Nervous System.—Very characteristic for plague is the intense and early disturbance of the mental condition. The patient presents the characteristics of alcoholic intoxication, thick speech, lack of mental concentration and giddiness which causes a staggering gait. Later on an apathetic or stuporous stage may ensue or there may be delirium.
Rarely a case of bubonic plague may show marked involvement of the meninges, giving the clinical picture of meningitis.
Circulatory System.—The pulse is at first soft, dicrotic and rapid, 110 to 120 beats per minute. Later on, as the heart begins to show the toxic effects of the disease, the pulse becomes thready and irregular, to be followed by cardiac failure.[204] There is a marked tendency to congestion of various internal organs and to haemorrhages from the capillaries.
Respiratory System.—Pulmonary congestion and even broncho-pneumonia may supervene in bubonic plague. In pneumonic plague, however, the lungs seem to be the primary seat of the bacterial development. Plague pneumonia is characterized by intense toxaemia and few physical signs. The abundant, watery sanguineous sputum is loaded with plague bacilli. Dyspnoea and cyanosis appear early.

The Lymphatic System.—It is the presence of the plague bubo which differentiates bubonic plague. There is no relation between the size of the bubo and the severity of the attack. Axillary buboes are the most fatal. A characteristic of these buboes is their extreme tenderness, the pain causing the patient to draw up the legs or assume any attitude which will relieve tension upon the bubo. The size is mainly due to the periglandular infiltration or oedema, which causes the glands of a group to be matted together.
The elevation of a plague bubo is rather diffuse, not pointed as with venereal buboes. Femoro-inguinal buboes are about 6 times as frequent as cervico-maxillary ones. There may be lymphangitis as well as lymphadenitis.
Cutaneous System.—The skin over the buboes often tends to become necrotic and slough off. This however may occur elsewhere and such lesions are termed[205] “carbuncles.” Capillary haemorrhages of the skin may cause petechiae and when the area is large they have been designated “tokens.” In about 5% of cases there is a small vesicle or pustule at the site of the flea bite as an indication of reaction. The contents teem with plague bacilli. It is often termed the primary lesion.
The Liver, Spleen and Alimentary Tract.—The spleen may show enlargement and tenderness on deep pressure, as may also the liver, these organs being markedly congested. The tongue at first is coated, with clean tip and sides. Nausea and vomiting frequently occur and, as a rule, there is constipation. Haemorrhages from the bowel may occur.
Diagnosis
Clinical Diagnosis.—It is well to remember that we have a sure and simple means of diagnosis by bacteriological means so that in the first cases during an epidemic we should rest the determination of the case as one of plague solely upon such methods.
One should be suspicious of any case of fever of rapid onset in which there is marked dulling of intellect and impairment of speech, as of one intoxicated, together with evidences of rapidly developing heart weakness. In septicaemic plague we practically have no other symptoms to guide us—there is not the exquisitely tender bubo of bubonic plague nor the abundant, watery, sanguinolent sputum of pneumonic plague.
Typhus fever probably more nearly resembles plague at its onset than any other disease. There is marked clouding of the consciousness and intense prostration as with plague and the eruption does not appear before about the fourth day.
An influenza pneumonia may show the general prostration and cardiac weakness of plague. In influenza pneumonia we have an onset with the features of ordinary influenza, which, however, in the influenza epidemic in 1918 was often short. In plague pneumonia we have pneumonia from the start. The pulse in plague is early weak and rapid and the tendency to a stuporous state more marked. The early appearance of thin watery sputum, which quickly becomes blood-tinged and always contains plague bacilli is noted in plague pneumonia. Only a few hours elapse before we have bloody sputum which in influenza is a later and not constant sign. The dyspnoea is earlier and much more pronounced in the pneumonic plague. At autopsy Crowell notes the almost invariable presence of pleural exudates in plague while an acute vesicular emphysema is a feature of influenza pneumonia.
Malaria and septicaemic conditions may be confused with septicaemic plague. The sudden onset and prostration of relapsing fever may make one think of plague.
Many have thought climatic bubo a form of ambulant plague but the gradual onset, only slight tenderness of the swollen glands and slight prostration should differentiate. Venereal bubo cases are apt to be regarded with suspicion during epidemics.
Markedly toxic cases of typhoid fever with an exceptionally rapid onset may give rise to confusion.
Laboratory Diagnosis.—If the patient has a bubo we should introduce a hypodermic syringe needle into the swollen, oedematous glandular mass in order to obtain some of the gland juice. Smear a drop of this on a slide, stain with Loeffler’s blue or dilute carbol fuchsin and examine for bipolarly stained oval bacilli. When the bubo begins to soften we may not obtain plague bacilli.
Probably the best stain for plague bacilli is that recommended by Archibald. There are two solutions, one made by dissolving 0.5 gram of thionin and 2.5 grams phenol crystals in a 1% aqueous solution of formalin; the other solution is made by dissolving 0.5 gram methylene blue and 2.5 grams phenol crystals in a 1% formalin solution. Let these stock solutions stand 24 hours before using and then mix equal parts of each solution; filter, and stain smear for 10 seconds. Wash and dry.
In a case of suspected pneumonic plague we stain the smear of watery or thin blood-tinged sputum as above.
The same procedure may be followed with a rather heavy blood smear of a drop of the 5 or 10 cc. taken from a vein for culturing in a case suspected of septicaemic plague.
Plague is practically the only bacterial disease where there is likelihood of finding the causative organism in smears. In septicaemic plague the blood culture is the proper procedure and one should take 5 to 15 cc. of blood in 15 to 25 cc. of normal saline containing 1% of sodium citrate. This prevents coagulation and at one’s leisure 1 or 2 cc. can be added to tubes of melted agar and plates poured or other portions added to bouillon or 3% salt agar. This same blood emulsion can be used to infect guinea pigs subcutaneously or to infect them cutaneously by rubbing on the shaven surface.
In smears from material from buboes, from sputum, or in blood smears, as well as from blood or spleen smears from experimental animals, we obtain the typical morphology of a cocco-bacillus (1.5 × 0.5 microns) with very characteristic bipolar staining, there being an intermediate, unstained area. Very characteristic also is the appearance in these smears of degenerate types which stain feebly and show coccoid and inflated oval types. The presence of these involution forms associated with typical bacilli is almost diagnostic for one with experience. Inoculating tubes of plain agar and 3% salt agar with this same material, we obtain in plain agar cultures organisms which are, typically, small, fairly slender rods, which do not stain characteristically at each end and are not oval. The smear obtained from the salt agar presents most remarkable involution forms—coccoid, root-shaped, sausage-shaped forms, ranging from three to twelve microns in length, more resembling cultures of moulds than bacteria. Another point is that on the inoculated plain agar we are in doubt at the end of twenty-four hours whether the dew-drop colonies are really bacterial colonies or only condensation particles. By the second day,[207] however, these colonies have an opaque grayish appearance, so that now, instead of questioning the presence of a culture, we consider the possibility of contamination.
Blood cultures in septicaemic plague may show from 5 to 500,000 bacilli per cc. Smears from the blood in such cases are positive in only about 17%.
The plague bacillus grows well at room temperature—its optimum temperature being 30° instead of 37°C., as is usual with pathogens. Next to the salt agar culture, the most characteristic one is the stalactite growth in bouillon containing oil drops on its surface. The culture grows downward from the under surface of the oil drops as a powdery thread. These are very fragile, and as the slightest jar breaks them, it is difficult to obtain this cultural characteristic.
Albrecht and Ghon have shown that by smearing material upon the intact, shaven skin of a guinea pig, infection occurs. This is the crucial test. Smear the material on a shaven surface about 1 inch square.
A pocket made by cutting the skin of a guinea pig with scissors and extended subcutaneously with scissors or forceps, into which a piece of the suspected plague tissue is thrust with forceps, is more practical than injecting an emulsion with hypodermic syringe.
Mice inoculated at the root of the tail succumb quickly. Rats, this being primarily a disease of rats, are of course susceptible.
When a guinea pig is inoculated with plague material the animal should be placed in a galvanized iron garbage can or other similar container and the opening covered with cheese cloth to prevent the fleas or other vermin which it might harbor from escaping. Again a 6-inch band of tanglefoot fly paper should be attached around the interior of the upper part of the can to further prevent escape of fleas. It must be remembered that every precaution must be taken in the laboratory to prevent the escape of plague-infected fleas. The guinea pig usually dies in from two to five days and shows glandular enlargements, and marked congestion of viscera with a swollen spleen, smears from which may show a profusion of plague bacilli.
The subcutaneous tissues about the site of inoculation show a haemorrhagic oedema.
If guinea pigs are not available one may use white mice which die within forty-eight hours or white rats which live about as long as guinea pigs.
One of the most important points in fighting plague is the detection of plague in the rats and, from noting the locality in which such plague-infected rats were caught, to direct our rat destruction efforts to that particular section of the city. These dead rats should be dropped into a bichloride solution or petroleum preparation in order to destroy the rat fleas. In the laboratory they are dissected and plague-infected ones most easily recognized by the marked subcutaneous injection of the widely reflected skin flap. Oedematous or haemorrhagic glandular swellings are characteristic. The liver shows a yellowish appearance, and as if sprinkled with[208] small whitish dots and the spleen is swollen and congested. There may be effusion into the pleural cavities. Material from the swollen glands or spleen should be stained, cultured and inoculated into animals as for a human case.
If glandular, splenic or other material from human or rat autopsies has to be sent to a distant laboratory the specimen should be placed in a strong salt mouth bottle containing 20% glycerine in water with 2% calcium carbonate.
Agglutination is not very practical owing to the frequent absence of agglutinins from the serum of plague patients. Then, too, there is a marked tendency to spontaneous agglutination on the part of the plague bacilli. Strong states that culturing at 37°C. lessens this tendency to spontaneous agglutination. Again, even when present, the titre of plague-agglutinating sera is usually quite low so that one must work with dilutions of from 1 to 10 or 1 to 20.
Prognosis
Pneumonic and septicaemic plague give an almost absolutely unfavorable prognosis, many stating that every such case dies.
As regards bubonic plague the mortality averages 75%. The Egyptian epidemic of 1900 gave an average mortality of 50%. The mortality in natives is much higher than that among Europeans, these latter often showing death rates under 25% while in the same epidemic natives show from 75% to 95% mortality. Plague pneumonia, however, is absolutely fatal for Europeans as well as natives.
Prophylaxis and Treatment
Prophylaxis.—In pneumonic plague it is the human patient and not the rat which has to be considered. The infection is spread by means of droplets of plague bacilli-laden sputum which are sprayed from the mouth of the patient in the act of coughing. As a result any person entering a ward containing plague pneumonia cases is extremely liable to contract the pneumonic form of plague.
The attendants are protected by bag-like masks or successive layers of gauze and cotton wool applied as bandages over face and neck. Motoring goggles make a good protection for the eyes and small rolls of cotton should be placed along the sides of the nose to absolutely prevent the possibility of bacilli being drawn down to the entrance of nose or mouth. These masks should not have any weak spot in their armor.
Spread of plague pneumonia.—It has been noted that when secondary pneumonia develops in the course of bubonic plague in India, the Philippines, or other hot countries, it is not followed by primary plague pneumonia outbreaks. This is thought to be due to the fact that the windows are wide open and the relative humidity[209] low, conditions which are the opposite of those which existed in Manchuria where the intense cold made the closing of windows necessary and where the air of rooms or wards was saturated with the moisture from the occupants. As the main consideration for the spread of pneumonic plague seems to be high relative humidity it would seem that hospital wards could be constructed so that the air supplied by artificial ventilation would be very dry.
The recent outbreak of septicaemic plague in Ceylon at a time when there was no plague noted in rats would indicate that other transmitting agents than infected rat fleas were operative. The most probable transmitting insects to be suspected would be the bedbug and human flea.
Spread of bubonic plague.—With bubonic plague, unless it should in its course become pneumonic or septicaemic, there is almost solely the question of the rat and its fleas. Many authorities consider that pure bubonic plague can be treated safely in a general ward of a hospital provided there is sure freedom from bedbugs or other verminous insects.
The various species of fleas which the rat may harbor may be attacked by the use of various petroleum preparations containing naphthalene. One preparation known as pesterine, which consists of kerosene 20 parts, soft soap 1 part and water 5 parts, the soap being dissolved in the water and the oil being gradually stirred into the hot mixture, is often recommended as a flea insecticide. A 5% solution of compound cresol to which naphthalene has been added is also of value.
It is always well to combine flea destruction with rat extermination because, as rats are reduced in numbers, there are fewer hosts, so that man is more liable to infection with fleas deprived of a sufficient number of rat hosts.
This may explain why a high death rate among rats, as the result of a plague epizootic, may act as a factor in the outbreak of human plague.
Rat destruction.—As a matter of fact, however, it is best to attack the problem from the side of rat extermination which, it must be understood, is most difficult owing to the highly developed suspicious nature of the rat. A successful rat catcher or rat exterminator must have the mind of a detective.
The first measure in rat extermination is the regulation of the disposal of garbage. It is most important that only cans with securely fitting tops be used so that rats cannot secure any food from the contents of the can. Again no particle of food should be left accessible to the rat. Unless the ordinary food supply of the rat is denied him he will not eat poisoned bait or bait in traps. Again rats are not only carnivorous but will eat any kind of cereal or vegetable, in fact they will eat almost anything and in addition are cannibals. In a plague outbreak especial attention should be directed to flooring in stables, under surfaces of board walks, sealed-in[210] attics of houses, wharves and sewers. Where sewers have catch-basins at street openings the rat has a means of egress from the sewer. These sedimenting catch-basins also serve as a breeding place for mosquitoes. It has been estimated that a sewer rat can jump 2 feet but not 3 feet.
In rat-proofing houses, double walls should be eliminated and houses raised well from the ground—at least 18 inches. In plugging up rat holes with concrete we should add broken glass to the concrete. Sheets of galvanized iron driven down several feet have been used as a protecting barrier around grain elevators or warehouses. Concrete is the proper material to use in rat proofing.
Where rats are on board ship fumigations with sulphur dioxide, carbon monoxide or funnel gases are usually employed.
Hydrocyanic acid gas is a most efficient destroyer of rat and flea life. The great objection to its use is its danger to those using it in fumigation. Liston allows this gas, developed from ½ ounce KCN, to act for four hours in a space of 100 cubic feet. The great danger from the use of this gas in holds of ships is that it tends to collect in detached spaces or pockets and remains following ventilation of the hold so that persons entering such spaces suffer the poisonous effects of the gas. Some cargo ships have a rat-run built to extend fore and aft and leading to a receptacle in which the rats are caught. Rats naturally choose a tube or similar opening so they get into this little passageway which is so constructed that their return is obstructed. This scheme is used in setting traps, either covering the traps with hay and leaving a small opening or placing the trap under an inclined plank or placing it at the end of an iron or terracotta pipe. There is not much danger of rats getting aboard a ship lying out from the dock. It is when a ship goes alongside a dock that we can expect rats to come aboard.
Phosphorus paste made up with a glucose base and containing about 4% of phosphorus is spread on pieces of stale bread, 1 inch square and ¾ inch thick. Whatever poison is used, whether strychnine, arsenic or phosphorus, it should be placed in boxes which have openings large enough to let the rats in but too small for domesticated animals. Barium carbonate is a useful rat poison.
Cats will very rarely attack the fierce sewer rat.
Danysz virus.—Many workers, during plague outbreaks, have tried to exterminate rats by impregnating bread or other bait with bacterial cultures. The best known of these viruses, as they are called, is that of Danysz. The organism is closely related to B. enteriditis of Gaertner and is supposed to bring about a fatal infection in the rats. As a matter of fact the cultures quickly cease to be virulent and their use has been generally abandoned. Simpson, however, thinks well of this measure and employed it with success in South Africa. He kept up the virulence of his cultures by frequent passage through animals.
In rat extermination it is advisable to employ Heiser’s Manila plan. In this, the location in the city of the plague rats brought into the laboratory is noted and radiating lines made from such foci. Plague-infected rats are rarely found more than a few squares from the focus. The periphery of the infected area is then considered as an outer zone[211] for the fight and the house-to-house extermination is carried on toward the center of the area. If, on the other hand, one should start at the center and work peripherally the infected rats might be spread all over the city.
Prophylaxis by Immunization.—The best-known bacterial prophylactic is that of Haffkine. Stalactite bouillon cultures are grown in flasks for five to six weeks. The organisms are then killed by heat at 65°C. for one hour. Phenol (½%) is then added and from 0.5 to 4 cc. injected according to the age and size of the individual. Ten days later a still larger amount is injected. The reaction following these injections is apt to be quite severe.
Recent reports show that of 118,148 inoculated persons the plague incidence was approximately 8 per 1000 while among 321,621 noninoculated the incidence was 34 per 1000.
Statistics from Sagaing show 19 cases with 7 deaths among 4284 inoculated persons while there were 134 cases and 128 deaths among 4467 not inoculated.
The plague mortality in cases which had previously been inoculated was 40% while that among the noninoculated was 78%.
From the above it will be seen that incidence is reduced to about one-fourth and mortality about one-half as the result of the use of Haffkine’s prophylactic.
Besides this killed culture other material has been used. Lustig and Galleotti used the nucleo-proteid from plague bacilli for subcutaneous injection. Kolle and Strong have recommended a vaccine of living but nonvirulent plague bacilli. A higher degree of immunity seems to be conferred by this living vaccine but there are certain dangers in the use of living organisms which outweigh the advantage noted above.
Yersin’s antiplague serum, which is prepared by injecting horses at first with killed cultures and later with living plague bacilli, may be used as a prophylactic as well as in treatment. One point to consider is that such serum, if used immediately after taking from the horse, might contain living plague bacilli. The phenol preservative prevents this. It must be remembered that this is a passive immunization as against the active one with Haffkine’s prophylactic, hence the protection is very short, only ten days or two weeks as against the more enduring immunity of a year or so following Haffkine’s prophylactic. It must be remembered that anaphylactic manifestations may follow the repeating of the dose of Yersin’s serum. It is probably advisable for one who is to be exposed to plague for a short time only to receive an injection of the serum. As regards pneumonic plague there seemed to be little protection attaching to either active or passive immunization.
Treatment.—It may be stated that the only treatment which has any curative value is that with antiplague serum. This would appear[212] to be of considerable value in bubonic plague provided it is administered in the first day or two of the disease. It must be given in large amounts, from 50 to 100 cc. or even to the extent of 250 cc. Then too such enormous doses apparently require to be repeated. Intravenous administration gives a better chance for success in desperate cases. In septicaemic and pneumonic plague the use of serum has been without result.
Salvarsan, as might be expected, has been tried but did not prove of any value.
Connor has reported success with the intravenous injection of one dram of a dilution of 1 part of tincture of iodine in 10 parts of sterile water. He gave 6 such injections to a severe case with good result.
In the way of symptomatic treatment one should use ice-bags to head and cold sponging to the body.
Morphine seems to be the best drug to calm the patient. Cardiac stimulants, especially strychnine, are indicated for the heart weakness so much a feature of plague. Some consider incision or enucleation of the bubo of value in treatment but it has always seemed to me that the going into the periglandular exudate might serve to set up a septicaemic condition when otherwise it might not supervene.
CHAPTER XIV
TULARAEMIA
Definition and Synonyms
Definition.—This is a plague-like disease of various rodents, transmissible to man, caused by an organism Bacterium tularense, which is not closely allied to any other species. A number of human cases have been reported from Utah, where the disease is prevalent among the jack rabbits, and the transmission to man is through the bite of a horsefly, Chrysops discalis, which has previously sucked the blood of infected jack rabbits.
The site of the bite in man is usually marked by a punched-out ulcer, which is associated with swelling and suppuration of the glands draining the area. The general symptoms are sudden onset, with rigors, followed by an irregular fever of three or four weeks’ duration and by a prolonged convalescence. Several cases have been reported in the middle west due to handling infected rabbits. There have been a number of infections in laboratory workers where the local signs have been absent. In man death rarely results from the disease.
Synonyms.—Deer-fly fever (in man). Plague-like disease (in rodents).
History and Geographical Distribution
History.—In 1911 McCoy and Chapin discovered the B. tularense in a plague-like disease, first described by McCoy in the California ground squirrel. They described the organism, succeeded in cultivating it on special media, transmitted the infection to various rodents by feeding, nasal inoculation and injection of infected blood, and demonstrated the probable natural mode of transmission by the squirrel flea.
In recent publications, Francis, Lake and Mayne, and Wayson have recorded the transmission of the disease experimentally by the house fly (Musca domestica), the horsefly (Chrysops discalis), the stable fly (Stomoxys calcitrans), the rabbit louse, the mouse louse and the bedbug, and have shown that the freshly recovered organism can be grown on other than the special media previously recommended.
Geographical Distribution.—The first case of infection occurring in man was reported from Ohio by Wherry and Lamb in 1914. Since then a number of cases have been reported by Francis among rural residents of Utah and by Francis and Lake among laboratory workers handling animals infected with B. tularense.
Etiology and Epidemiology
Etiology.—Bacterium tularense is a small nonmotile Gram-negative cocco-bacillus, from 0.3 to 0.7µ long and gives the appearance in stained preparations of being surrounded by capsular material. It is very difficult to cultivate and until recently it has been grown only on coagulated egg yolk as used by McCoy and Chapin.

Recently Francis has shown that the organism will grow scantily on serum or blood agar. However, by adding a piece of fresh sterile spleen to such media he has obtained a more satisfactory culture medium, although for routine work the egg yolk medium is preferred. The organism refuses to grow on ordinary media such as nutrient broth or agar. Material from a culture, or pus from bubo, or an emulsion of the spleen of an infected guinea pig, when rubbed into the abraded skin of an experimental animal brings about infection, in this respect showing a similarity to plague infection. Upon autopsy of such an experimentally infected guinea pig we find haemorrhagic oedema at the site of inoculation with caseation of lymph glands and small necrotic foci in spleen and liver. Smears from the spleen show the organism in varying numbers. In infected rodents the organism is often found abundantly in the blood and in man a bacteriaemia may occur.
Epidemiology.—The infection of ground squirrels with this organism was noted by McCoy in his plague work in California. Francis in studying the disease in man in Utah found infection of the jack rabbits and ground squirrels of the region and showed that the transmission of the disease could be carried out by a biting fly (Chrysops discalis) and[215] reported this fly as the common transmitting agent of the human infection. He regarded the sick and dying jack rabbits as the reservoir of virus. Tularaemia is chiefly a disease of the rural population attacking those at work in the fields.
As a result of accidental laboratory infections it would seem that almost 100% of those carrying on extensive animal experimentation with this organism become infected.
The louse infesting jack rabbits Haemodipsus ventricosus, can transmit the infection from rabbit to rabbit so that the infection in the jack rabbits is probably kept up by this agency. Recent experiments have shown that the infection in white mice can be transferred by the bites of the mouse louse and also by bedbugs. Again if the mice are fed on infected bedbugs transmission is found to take place by such feeding experiments. The faeces of such bedbugs prove infectious. Guinea pigs injected subcutaneously with the urine of white mice suffering from the disease die acutely with typical lesions of tularaemia.
Mice fed on the liver of a rabbit dying of the disease succumbed to the infection within five days.
As noted under etiology the most important method of spread of the disease to man is by the bite of an infected horsefly (Chrysops discalis). From experimental studies it would seem that any biting arthropod might prove a transmitting agent. In view of the fact that the infected deer fly tends to lose its infectivity after about five days Francis is of the opinion that the fly is only a mechanical transmitter of the organism.
Wherry reported the infection as manifested by conjunctivitis with glandular involvement and due to handling infected wild rabbits.
Lake and Francis have reported that of six investigators from the Hygienic Laboratory working with this infection all have contracted the disease. There were fortunately no fatalities. Such an experience demonstrates the great infectivity of this virus and must lead to the conclusion that the few cases so far reported of the disease do not represent the importance of tularaemia in man. With a knowledge of the existence of such an infection and with satisfactory methods of laboratory diagnosis we shall probably have other reports of the infection. We now know that the ground squirrels of California and Utah, the jack rabbits of Utah and the wild rabbits of the middle west furnish important reservoirs of virus.
Pathology
In experimental animals we have lesions which cannot well be differentiated from those of plague. There is not sufficient data for a statement as to the pathology in man.
In experimental animals we have a definite bacteriaemia but in man the organism has only in rare instances been obtained from the blood.
Symptomatology
It has been difficult to determine the period of incubation but in one laboratory infection the disease set in seven days after the patient began tularaemia work. There do not seem to be any prodromata.

In Utah most of the cases showed local lesions at the site of the fly-bite and subsequent swelling and suppuration of adjoining lymph glands. The local lesions were generally observed about the head or on parts of the body not covered by the clothing. There is a rather sudden onset with chilliness or rigors, generally associated with dizziness, prostration and malaise. Headache is usually present and there may be complaints of pains in the back and limbs. The temperature rises rapidly and when first taken during the rigors may reach 103° or 104°F. An irregular fever course follows for two or three weeks. There is practically no apathy, thus differentiating the mental state of typhoid fever or the marked clouding of the consciousness of plague. At times we may have rhinitis and epistaxis.
Physical examination is almost invariably negative. The spleen is not palpable. The pulse is rather rapid and the blood pressure uninfluenced.
The white and differential counts vary but little from normal.
The main feature of the disease, aside from local lesions when these are present, is prostration and this continues marked during the several weeks or months of convalescence.
It is a disabling illness rather than a dangerous one though a fatal case is recorded.
In the six laboratory infections above referred to, there were no local lesions except in the case of one man who had had previously an attack of the disease. In the second attack, two years after the first one, there was noted a papule on one finger with subsequent involvement of the epitrochlear and axillary glands. A guinea pig inoculated with blood taken from the papule became infected and showed the typical lesions of tularaemia.
There was no fever or malaise in this second attack, thus showing a degree of immunity. In cases showing conjunctival ulcerations with glandular involvement Wherry and Lamb obtained cultures of B. tularense from inoculated animals.
Diagnosis
There is very little in the clinical picture, other than the local lesions, to indicate a diagnosis.
Material from ulcers or glands should be inoculated into guinea pigs or white mice. The organism is almost invariably absent from the blood of human cases so that blood cultures or animal inoculation from such blood are almost always negative.
Complement fixation and agglutination tests are the methods of diagnosis to be relied on. In the Hygienic Laboratory an antigen is prepared by washing off the 72 hour growth from egg yolk medium with small amounts of saline. The suspension is heated for 30 minutes at 56°C. and then preserved by the addition of O.3% tricresol. Such an antigen is used for each type of test.
Prognosis
This disease is but rarely followed by death. It is however a most incapacitating disease by reason of the three or four months of convalescence during which time the strength and energy of the patient are markedly affected.
Prophylaxis and Treatment
Prophylaxis.—In view of the very great liability to infection of those carrying on autopsies of animals experimentally infected with the disease it would seem advisable to wear rubber gloves when doing such work. It would appear that house flies, stable flies and horseflies may transmit the disease in nature and we know that bedbugs and lice can transmit the disease among experimental animals. When we consider the natural infection of ground squirrels and jack rabbits in California and Utah and wild rabbits in the middle west, the problem of prophylaxis looms to great proportion.
Treatment.—At present treatment is entirely symptomatic. Those who go to bed at once and remain in bed during the stage of fever seem to be less seriously affected.
CHAPTER XV
CHOLERA
Definition and Synonyms
Definition.—Cholera is a disease caused by a spirillar type of bacterium, Spirillum cholerae asiaticae. The organism multiplies in the small intestines and, undergoing lysis, liberates an endotoxin, which is responsible for the desquamation of the epithelium of the mucosa and other manifestations of the disease. Cholera appears to be endemic in the delta of the Ganges and the various world-wide epidemics can generally be traced to that source. The rice-water stool of cholera teems with the spirilla, and infections of water or food supplies can be traced to such a contamination. The importance of the cholera carrier has been thoroughly demonstrated from the time of the Hamburg epidemic of 1892. The clinical course of the disease is divided into a stage of evacuation, in which we have diarrhoeal discharges of rice-water character along with very painful cramps of the muscles. Following increasing cyanosis we have almost a cessation of circulation often associated with anuria, the algid stage. With the return of activity of circulation and urinary secretion we have the stage of reaction.
Synonyms.—Cholera Asiatica.
History and Geographical Distribution
History.—Although the word χολέρα, meaning flow of bile, is found in the writings of Hippocrates, it certainly does not refer to the disease we now recognize as cholera. The older writers noted the characteristics of bilious discharges in the disease they termed cholera, which could not apply to the bile-free rice-water discharges of what we now term cholera. Koch rather doubted the antiquity of cholera but Susruta, in India, in the 7th century A. D., described a disease in which there were diarrhoea and vomiting, stabbing pains, cyanosed lips and nails, with sinking in of the eyes and weak voice.
Detailed accounts of the presence of cholera in India were published from the 16th to 18th centuries when the Portuguese, English and French were carrying on their wars of conquest in India. These wars naturally spread the disease all over India.
It is thought that true cholera did not exist in China until 1669 when it was carried there from India. It is first described from Japan in 1821 although an epidemic which devastated Tokyo in 1718 may have been cholera.
A great pandemic of cholera started in India, in 1817, extending over Asia but not invading Europe. The second great pandemic is of importance as being the first to invade Europe. It started in India in 1826 and advancing slowly reached Persia in 1829, going thence by way of Astrakhan to Russia, Sweden, Northern Europe and England. By 1832 it had spread over the whole of Europe.
In the same year, 1832, it reached Canada and thence spread to Fort Dearborn where it infected the soldiers who subsequently carried the disease down the Mississippi valley. It was also introduced into New York and spread thence South and West so that by 1836 cholera was present all over the U. S., not disappearing until 1838. It disappeared from Europe in 1839.
The next European outbreak or third pandemic lasted from 1846 to 1862 and was traced to India by way of land and sea, that by land following the caravan route by way of Persia and Russia and that by sea from Indian pilgrims going to Mecca and there causing the infection of Mahommedan pilgrims from Egypt and European Turkey. This pandemic reached the U. S. in 1848, starting at New Orleans and going up the Mississippi valley. Central and South America and the West Indies were also invaded by the third pandemic.
The fourth great pandemic invaded Europe by the usual routes and continued from 1863 to 1875. During its continuance there were two outbreaks in the U. S., one in 1867 and another in 1873.
That in 1873, when it was introduced into three widely separated parts of the country, was the last appearance of cholera in the U. S.
The fifth pandemic began in 1883 and affected particularly the Mediterranean seaports of France, Spain and Italy. It was during this epidemic, in 1883, that Koch, working in Egypt, discovered the cause of cholera, the Spirillum cholerae asiaticae.
A very serious outbreak of cholera, which originated in 1891, in pilgrims from the delta of the Ganges, reached Europe in 1892, almost a million deaths occurring in Russia. It was during this epidemic that cholera appeared in Hamburg and gave opportunity for those careful studies as to transmission of the disease to be later referred to.
It is usual to recognize a sixth pandemic which began in 1902 and spread over India, China and the Philippines. This pandemic continuing was a cause of great mortality among the soldiers of the recent Balkan war. During the World War there was much cholera among the Austrian forces in Galicia. It also prevailed in Bulgaria, Greece and Turkey.
Geographical Distribution.—Practically every pandemic when studied can be traced back to India and particularly to the delta of the Ganges, which may be considered the enduring focus of the disease.
Etiology and Epidemiology
Etiology.—The cholera vibrio, Spirillum cholerae asiaticae, was discovered by Koch in 1883 and is a short curved organism which, from its shape, is often called the comma bacillus. In addition to single spirilla there may be “S” shapes from attachment of pairs. In cultures in peptone solutions long filamentous forms may be seen which however are exceedingly rare in the rice-water stools. A stained smear from a fleck of mucus gives the fish-in-the-stream appearance. Besides comma-shaped organisms we may have coccoid or rod-shaped forms. In old cultures marked pleomorphism is often seen.

It is Gram-negative and stains best with a dilute (1-10) carbol fuchsin. There is a single terminal flagellum, which endows the organism with great motility, which may best be termed scintillating. It has been estimated that its motility is five times greater than that of the typhoid bacillus. It grows best on media with an alkaline reaction (—0.4%) and it is this tolerance for media of high alkalinity that permits the separation of the cholera spirillum from the ordinary faecal bacteria by the use of Dieudonne’s alkaline blood agar or similar media. This is equal parts of defibrinated ox blood and N/1 NaOH, 3 parts of which are added to 7 parts of nutrient agar. It thus has 15% of normal sodium hydrate, instead of the 1% acid reaction of the usual media. Unfortunately, other spirilla tolerate this high alkalinity.
The cholera organism is strongly aerobic and grows quickly and luxuriantly in the upper part of a tube of Dunham’s peptone solution, this property enabling one to[221] separate it from other organisms of faeces by taking up loopfuls from the surface layer to plate out on agar of about 0 or -0.3% reaction. When grown in peptone solution the cholera spirillum produces a nitroso body so that one obtains an indol reaction (cholera red) by simply adding 5 or 6 drops of concentrated H2SO4.
When this test is employed it is necessary to determine whether the peptone used is suitable for the reaction. As a matter of fact this test is now rather discredited. Blood serum is digested. Recently much discussion has arisen as to the value of the haemolytic power possessed by noncholera vibrios on blood agar plates.
It is true that the digestive action which true cholera has on the red cells of the medium may give the appearance of a zone of haemolysis. Therefore, for the demonstration of this haemolytic action of noncholera spirilla, fluid blood media should be used. The El Tor spirillum, isolated from Egyptian pilgrims without symptoms of cholera, is haemolytic, but gives the immunity reactions of the true cholera vibrios which are not haemolytic.
Gelatine is liquefied and the stab shows an air bubble liquefaction at the summit of the stab. On gelatine plates a powdered glass center with an encircling zone of liquefaction was formerly considered characteristic of cholera, but at the present time gelatine cultures have been almost abandoned in practical work.
As a rule animals cannot be infected by feeding them cholera material unless the acidity of the gastric juice be neutralized and intestinal peristalsis checked by opium (procedure of Koch). Injected intraperitoneally, the cholera vibrio produces a fatal peritonitis. Recently monkeys have been infected after purgation with sulphate of soda and administration of bicarbonate of soda. They died in from one to forty-eight hours with symptoms of cholera.
There have been instances where cholera has been caused in laboratory workers by the accidental ingestion of cholera cultures, thus Orgel was infected from sucking up peritoneal fluid in doing Pfeiffer tests for bacteriolysis and died.
Emmerich and Pettenkofer swallowed cholera cultures, the former experiencing a severe attack of cholera and the latter a diarrhoea in which cholera spirilla were present. On the other hand similar experiments have resulted negatively but this is what should be expected from the epidemiological facts as to carriers.
The virulence of the cholera vibrio can be exalted by passage through guinea pigs—successive culturing of the peritoneal exudate of intraperitoneally infected animals alternating with culture media growth inoculations. Such a fixed virus, the virulence of which cannot be exalted, is the material used by Haffkine in his cholera vaccine. The toxicity of cholera is supposed to be due to an endotoxin which is set free when the vibrios undergo disintegration when lying between the basement membrane and epithelial lining of Lieberkühn’s glands. Others think the vibrios may enter the blood stream, there to be immediately disintegrated with toxin production. The usual idea, however, is that the cholera spirilla never invade the blood stream—they are confined to the alimentary canal. Macfadyen obtained the endotoxin by grinding the frozen spirilla. This toxin was destroyed by a temperature of 60°C.
The spirillum of cholera has but little resistance to disinfecting agents or to drying. It is also rapidly overgrown by putrefactive bacteria and tends to disappear from sewage-contaminated water in a short time. In stools the vibrio dies in about one or two days in summer and in about a week in winter.
The inoculation of animals by cholera cultures tends to produce an immune serum which is remarkable for its high agglutinating power, the titre at times going as high as 1 to 20,000. For agglutination tests in proving spirilla isolated from stools to be true cholera ones we use a serum of at least 1 to 4000 for its specific vibrio. Such a serum should agglutinate any true cholera spirillum in a 1 to 500 or 1 to 1000 dilution. The occurrence of bacteriolysis, when a small loopful of the culture emulsified in 1 cc. of 1 to 1000 dilution of the immune serum and then introduced into the peritoneal cavity of a guinea pig, is the surest proof that a suspected organism is that of cholera.
This is shown when, upon removing a drop of the peritoneal fluid fifteen to twenty minutes afterward, there is noted an absence of motility and disintegration of the spirilla (Pfeiffer’s phenomenon).
Complement fixation tests, using the rice-water stools or peptone solution cultures as antigen, are of less value than those above noted. Agglutination is the practical test and is almost as specific as that for bacteriolysis.
Epidemiology.—Until recently our attention as to the methods of transmission of cholera was directed almost exclusively to the water and food supply, with a certain degree of consideration of danger from fomites, especially to that connected with clothing soiled by cholera discharges, it having been noted that those who wash such clothing showed a high incidence of infection. Later on the importance of flies in the spread of the disease was strongly insisted upon. At the present time we consider the cholera carrier the most important factor in cholera epidemiology and it is to the detection and isolation of such persons that we now chiefly direct our attention in the keeping out of a country of this dread disease.
It will be remembered that Pettenkofer and Emmerich insisted upon the factors of soil and ground water in the spread of cholera. Emmerich now admits that the spirilla excreted by carriers can produce cholera but that such transference never gives origin to epidemics. For this to take place he thinks that the vibrios excreted by a carrier must come in contact with a soil which has been impregnated with a suitable medium drawn to the surface from the deeper layers of the soil by capillary suction. In such medium the vibrios flourish and acquire the property of actively producing nitrites from nitrates.
Emmerich considers that the symptoms of cholera are those of nitrite poisoning so that only such organisms as possess this nitrite-forming function in high degree can produce virulent outbreaks of cholera.
All facts in connection with the spread of cholera by land or water routes can be best explained by the cholera carrier; the individual who is excreting vibrios, while in apparent health, being far more dangerous than the one excreting such organisms in the rice-water stools of a well-recognized case of the disease.
Water Transmission.—There are two types of outbreaks of cholera according as the general water supply is contaminated or when such contamination is localized to certain wells, cisterns or other nongeneral supplies. In the former the onset is explosive and cases occur almost simultaneously and with equal distribution in all parts of the city, to disappear with almost equal suddenness.
In the latter mode of infection, cases will appear from day to day and often peculiarly localized to certain definite districts of a city or to certain definite users of a particular water supply.

Fig. 73.—An instructive contrast between Altona and Hamburg before the latter filtered its water, having learnt its lesson from a sharp outbreak of cholera. (After G. E. Armstrong.)
As an example of the first type of outbreak the Hamburg epidemic of 1892 is most instructive.
During a period of only about two months cholera attacked about 17,000 persons causing 8605 deaths in a city with a population of 600,000. This outbreak was attributed to the washing of clothes in the water of the Elbe River by Russian immigrants. These immigrants had come from cholera-infected districts and among them there undoubtedly were cholera carriers.
The water supply of Hamburg was taken directly from the river. The adjoining city of Altona, with a population of 140,000, is further down the river but filtered its water by a slow sand process. Although the water as taken from the river contained the sewage of Hamburg yet there were only 328 deaths or 2.1 per thousand as against 13.4 per thousand for Hamburg. There were many interesting points in connection with the exemption of certain places in Hamburg, of which may be noted the instance of the entire freedom from cholera of a group of houses (Hamburg Hof), with 345[224] occupants. This was the only section of Hamburg which was supplied with Altona water. As Hamburg and Altona are only separated by the width of a street and hence practically form a single city, the factor of food and contact transmission could easily explain the cases in Altona.
To illustrate the second type of water transmission we have the well-known incident of the Broad Street pump.
This was about the first definitely proven connection between water and cholera. In 1854 it was noted that cholera was about 10 times as prevalent in Golden Square as in other adjacent parts of London. Various factors, such as previous droughts, stagnation of lower strata of the atmosphere, sewerage defects and subsoil drainage were found to be the same in Golden Square as elsewhere. It was noted that the number of cases increased in the neighborhood of the Broad Street well. The employees of a cartridge factory where this well water was used gave a large number of cases while an adjoining brewery, which had a well of its own and served out beer to its employees, did not furnish a single case. Very striking was the case of a lady living at Hampstead, a section of London which was then free from cholera, who had acquired a liking for the water of this well and had brought out to her regularly bottles of water from the well. This lady drank some of the water on August 31 and was seized with cholera the next day. A niece drank of the same water and died of cholera as well as the aunt. A servant also contracted the disease but recovered.
Macnamara has noted the circumstance of a vessel of water, which became contaminated with cholera stools, but which at the time it was drunk by 19 persons did not show anything suspicious in odor, color or taste. One person was stricken one day afterward, two on the third day and two others came down with cholera on the fourth day. It will be noted that only 5 of the 19 were attacked. A similar lack of susceptibility of a certain proportion of people, equally exposed, has been noted in all cholera outbreaks. It is probable that of those of the 19 who did not contract cholera there were developed a certain number of cholera carriers.
Food Transmission.—Food contaminated by dejecta from cholera patients or carriers is dangerous in proportion to its condition of moisture. Drying and the development of inimical organisms are the two chief factors in destroying the cholera vibrio. Temperature and sunshine are operative in assisting the drying process.
Lettuce and celery are particularly dangerous because of the favorable condition of moisture in their folds and imbrications. Furthermore these vegetables are eaten uncooked and may have been fertilized with night soil (human excrement) which material, if containing cholera dejecta, would infect the plants. Milk is a splendid culture medium for cholera vibrios but, upon becoming acid, sterilizes itself of these vibrios. In sterilized milk, however, they live for extended periods, as long as sixty[225] days and, even when such milk is contaminated by faecal material containing other organisms besides the cholera vibrio, the vibrios live much longer than they do in raw milk.
Milk is liable to be contaminated by flies which have been in contact with cholera stools. Water that has been boiled and food that has been cooked should subsequently be scrupulously protected from flies or other contaminating agents. Uncooked shell fish are peculiarly dangerous in cholera outbreaks.
In India, sun-dried fish, which are frequently covered with flies during the curing process, are a factor in the spread of cholera.
Transmission by Carriers.—This is now universally recognized as the most important factor in the spread of cholera. Dunbar was the first to draw attention to the presence of virulent cholera spirilla in the faeces of apparently healthy persons during the Hamburg epidemic of 1892.
Since that time these observations have been generally confirmed. In some instances as many as 20% of those who have been in immediate contact with a cholera patient have become carriers, some showing symptoms of cholera but a larger proportion excreting cholera spirilla while continuing in health.
While cholera prevailed in Manila, McLaughlin found from 6 to 7% of carriers among healthy persons living in the infected districts.
Pottevin has recently reported that of 13,000 pilgrims examined 1.7 per thousand carried cholera vibrios. The carriers were especially common among the dysenteric patients. During the Naples epidemic of 1911 it was found that on the average 10% of healthy people in contact with cholera cases became carriers. It was estimated that 90% of the cases in this epidemic were infected by sick or healthy carriers.
Sergeant has recently reported the case of a healthy carrier who continued to excrete cholera vibrios for two months and during this time was in contact with 8 persons, 7 of whom became infected and 4 died. In Manila it was found that many of the children reported as dying of meningitis or infantile beriberi were cholera cases.
The vibrios are rarely excreted in the faeces of the cholera patients longer than seven to ten days. Frequently they disappear in three or four days.
With healthy cholera carriers the period of the continuance of vibrio excretion is equally short but cases have been reported where periods of from three weeks to two months have been noted. It is usually stated that 97% of carriers become vibrio free within a month.
Greig has found infection of the bile of the gall bladder or ducts in 80 cases in 271 cholera autopsies. When living organisms are injected into the ear vein of a rabbit they pass into the bile. An examination of the epithelial layers of the gall-bladder of such a rabbit shows destruction of the cells and the presence of vibrios in the underlying tissues. While cholera spirilla are soon crowded out by intestinal bacteria,[226] thus explaining the short period during which cholera spirilla are excreted by convalescents, this is not true when the cholera vibrio gets into the bile ducts or gall bladder. Greig found one cholera convalescent excreting cholera vibrios forty-four days after the attack. Of 27 persons who had been in contact with cholera patients 6 were excreting cholera vibrios although apparently well.
A very important matter is that persons who fail to show cholera vibrios may begin to excrete such organisms after the administration of a purgative or following some intestinal disorder. In fact purgatives may set up an attack of cholera in a cholera carrier.
The spread of cholera is intimately connected with the great religious festivals and pilgrimages of Oriental people. Not only do those of India keep up the dissemination of the disease there but pilgrims going from the delta of the Ganges to Mecca carry the infection and transmit it to their fellow pilgrims from Egypt and Algiers. Greig examined a number of cholera convalescents who were about to return to their homes in India and found 30 per cent of these pilgrims excreting cholera vibrios in their stools.
In India cholera accounts for about 1 to 1.5 deaths per 1000 of population. Malaria and plague are other great causes of death.
The intimate commercial relations between Europe and Egypt and Algiers make the introduction of the disease into European ports an easy matter. Of particular importance is the fact that so many sick people make pilgrimages, these being peculiarly liable to act as carriers.
Excesses in eating, often of badly prepared or decomposing food, following periods of religious fasts, predispose the natives of India to cholera.
Lowered resistance, as from disease or from gastric disorder, increases the susceptibility to cholera. Errors in diet and in particular the effects of alcoholic excesses markedly predispose to infection.
Pathology
The cholera spirillum does not produce a soluble toxin, the toxic principle being intracellular. The organism rarely penetrates more deeply than just under the epithelial layer of the glands of Lieberkühn. As a result of the outpouring of the fluid into the lumen of the gut we have an increase in the red cells (7,000,000 per cu. mm.) and leucocytosis of from 12,000 to 50,000. The specific gravity of the blood is greatly raised, 1073 to 1078, and the alkalinity diminished. The blood pressure is markedly lowered, 60 mm. in very severe cases and 75 mm. in less severe ones.
The lower portion of the small intestines is the favorite location for the action of the endotoxin of cholera. Early and marked postmortem rigidity is a striking characteristic of the cholera cadaver. Muscular contractions, causing odd positions[227] of the limbs, have at times given a basis for the idea that the victim had been buried alive.
Besides marked rigor mortis the emaciation, leaden hue of skin and shrivelled hands are noteworthy.
In opening up the body there is a striking dryness of all the structures. The dry and dark-red muscles stand out prominently. The lungs are dry and shrunken. The right heart is full of a dark, jelly-like, viscid blood. The leading changes are found in the abdomen. The omentum is dry, sticky and shrivelled looking. The intestines have a ground glass appearance with a lilac-pink color of the small intestines which is in contrast with the normal color of the large intestines.
There is congestion of the affected intestinal mucosa and the lumen is filled with the alkaline rice-water material. If the case is of some days standing we have a rather brownish, foul-smelling bowel content. There is usually a parenchymatous nephritis and on section the medullary portion is much congested.
Crowell gives the following points as indicating cholera upon autopsy: (1) Cyanotic finger nails, (2) dry tissues, (3) dry and sticky peritoneum with pink serosa of ileum, (4) contracted and empty urinary bladder, (5) shrunken dry spleen and liver, (6) rice-water intestinal contents and (7) prominence of lymphoid tissues in the ileum.
In his studies of the pathology of cholera Greig drew attention to the frequency of the involvement of the gall-bladder. He also noted the presence of small areas of consolidation in the lungs of those developing pneumonia during the early days of convalescence. In the exudates of such areas cholera vibrios could be seen thus showing their penetration of the lung. Although rare instances of recovery of the cholera spirillum from the blood have been reported Greig was unable to accomplish this in any instance. In his opinion the spirilla travel by way of the lymphatic system. In eight cases out of fifty-five cases he recovered the spirilla from the urine.
Symptomatology
A Typical Case of Cholera.—The so-called prodromal or premonitory diarrhoea is not a feature of the onset of cholera gravis, the type of the disease which characterizes the cholera epidemic.
The period of incubation is usually from one to five days. Longer periods are possibly explained by some exciting intestinal disorder in a cholera carrier. The course of the disease is conveniently divided into a stage of evacuation, an algid one and a stage of reaction.
The Stage of Evacuation.—A profuse and frequent diarrhoea comes on without colic or tenesmus. In fact the stools are voided with a sense of relief as when an enema is gotten rid of.
The striking feature, however, of these movements is the sensation of prostration which accompanies them.
The faecal character of these diarrhoeal stools is soon lost and the typical rice-water stool is now passed. This designation is very apt and the flocculi of intestinal epithelium, in a watery, slightly opaque fluid, suggests rice-water. The odor is slightly albuminous.
Early in this stage cramps of the muscles set in. The muscles of the legs, especially the calf muscles and those of the feet, are particularly liable to these very painful contractions which may cause the patient to cry out for relief. The muscles of the abdomen and back may also be involved as may at times the muscles of the entire body.
Vomiting, at first of the contents of the stomach and later of rice-water material, is a distressing feature to the patient and by reason of the manner in which it often gushes from the patient’s mouth is liable to contaminate the attendants.
Along with the excessive loss of fluid the tissues, especially of the face, become shrunken, the eyeballs with their congested conjunctivae sink back in the orbits, and the nose becomes pinched. The pulse becomes more and more feeble and there is a steady diminution in the secretion of urine. An increasing duskiness of the skin, which is cold and clammy to the touch, denotes the setting in of the algid stage.
Algid Stage.—In this stage there is almost complete cessation of circulation, even the incision of a vein is only followed by a drop of black tarry blood. Anuria is practically complete.
The vomiting, purging and cramps may or may not subside and in the patient, with his great thirst, intense exhaustion and cadaveric appearance, with mental faculties fairly well preserved, we have an example of a living death. The temperature of the sodden, inelastic, clammy skin is markedly depressed, even below 90°F., while the rectal temperature may approximate normal or be elevated.
Some authorities consider a marked difference between the superficial and rectal temperatures as of bad prognosis.
The voice becomes husky and finally so feeble that the patient can only whisper and the breath feels cold.
The sodden shrivelled hands, as those of a washerwoman, are very characteristic. Thirst is intense.
The patient now falls into a listless, motionless state in which, however, the apathy is more apparent than real. The algidity may deepen and death ensue or the stage of reaction may set in. The algid stage may last from a few hours to two or three days.
Collapse and uraemia are the two most frequent causes of death.
Stage of Reaction.—The pulse returns, urine is again secreted and the duskiness and coldness of the skin give way to normal conditions[229] and a favorable convalescence sets in. At other times, however, the rise of surface temperature and restoration of the circulation are not attended by urinary secretion.
In such cases a typhoid state ensues with accelerated respiration, dry, brown tongue and muttering delirium.
It is customary to divide the types of cholera cases into:
1. Cholera gravis. The type above described.
2. Cholerine. In this there is a more or less marked stage of evacuation with possibly the appearance of rice-water stools. The urine, however, does not become suppressed and the algid stage is not entered upon.
3. Cholera sicca. This type of the disease is more apt to be seen in old or debilitated people. The patient dies of collapse without showing symptoms of vomiting or diarrhoea. At the autopsy one may find the bowels distended with rice-water contents.
The so-called cholera ambulans is simply another designation for the more or less ill cholera carrier.
Sequelae.—Following an attack of cholera we may have abscess of the parotid gland or gangrene of various parts of the body. There may be ulceration of the cornea. In pregnant women the disease almost invariably causes abortion. Post-choleraic pneumonias and renal inflammations are to be considered.
Symptoms in Detail
General Appearance.—A typical case of cholera, with its cyanosed, drawn, pinched face, cold, clammy skin and the eyes deeply sunken in the orbits, makes a picture rarely seen in other conditions. The washerwoman’s hands appearance should always be looked for.
Temperature Record.—The temperature of the skin surface is lowered from the normal while that of the rectum may be normal or even elevated. There may be a difference of 10° or more between rectal and surface temperature. In the stage of reaction the temperature may continue to rise to high fever points and this so-called hyperthermic type is very fatal.
Circulatory System.—The pulse is rapid and feeble in the stage of evacuation to become imperceptible in the algid stage. The circulation is practically at a standstill so that only a few drops of black tarry blood, which does not coagulate readily, flow from a wound of a vein when giving an intravenous injection. The blood is concentrated and has a specific gravity of 1072 to 1078. The systolic pressure falls greatly, even to 60 mm. of mercury in a severe, or 75 mm. in a less serious case. The red cell count is increased to 7 or 8 million red cells per c.mm. and the leucocyte count reaches 15,000 to 50,000.
Nervous System.—The mind is clear, even when the patient seems profoundly apathetic. The muscle cramps are characteristic of the disease.
Diagnosis
Clinical Diagnosis.—It is customary to state that cholera nostras and infections with virulent meat poisoning bacteria of the paratyphoid group show bile in the intestinal discharges and not the typical rice-water stools of true cholera. It must be remembered that these affections can at times show as marked muscular cramps, emaciation, cyanosis and weak voice as cholera so that only the bacteriological examination can differentiate.
Algid pernicious malaria generally shows a rather high axillary temperature and the stools are rarely so profuse as in cholera.
In ptomaine or mushroom poisoning the vomiting usually precedes the diarrhoea—the opposite of the order in cholera.
Acute intestinal obstructions may simulate but here we have faecal vomiting and constipation.
With irritant poisons as arsenic or antimony there is the metallic taste and the pains are chiefly colicky rather than muscular and the stools rather dysenteric.
I have seen severe cases of bacillary dysentery which could not be differentiated clinically from cholera, and it is interesting to note that many cases of cholera occurring in the Balkan war were diagnosed as bacillary dysentery. In children cerebral manifestations are very common so that in the Philippines many such cholera cases were diagnosed as meningitis.
Laboratory Diagnosis.—Agglutination is the practical aid in diagnosis. The serum from cholera convalescents, or those vaccinated against cholera, show agglutinins. It has been stated that properly vaccinated cases show a titre of from 1 to 2 thousand in about 70% of cases. Normal human serum does not agglutinate in a higher dilution than 1 to 20. Greig has found that fatal cholera cases rarely give higher than 1 to 40. In cases recovering he found well-marked agglutinating power by the 6th day, titres of 1 to 500 or 1 to 1000 being frequently obtained. Janoue and Watanabe found the agglutinating power of the sera of convalescents to fall rapidly after the third week. As a rule the titre varied from 1 to 100 to 1 to 400. The highest titre noted was 1 to 10,000.
It is well to first make a microscopical examination of the stool by taking one of the whitish epithelial flakes from the rice-water material and making a straight smear which is then dried and fixed with heat. This may be stained best by a dilute carbol fuchsin (1 to 10). Methylene blue makes a good stain, or more differential is that by Gram’s method which shows the Gram-negative spirilla stained by the bismarck brown counterstain, giving the appearance of fish parallel to one another in a stream. According to Koch a diagnosis can be made in this way of one-half the cases during an epidemic.
The scintillating motility of cholera spirilla may strike one in the examination of the stool in hanging drop.
Dunbar has a quick diagnostic method in which epithelial flakes from the stool are emulsified in peptone solution. Then on a slide, according to the method to be later described, is deposited a drop of 1 to 50 normal serum dilution and on the same slide a second drop of 1 to 500 dilution of cholera serum. A loopful of the suspected stool emulsion is rubbed up in each of these serum dilutions and we should have cessation of motility and clumping in the cholera immune serum provided the organisms in the stool are true cholera spirilla.
In case of an autopsy on a suspected case of cholera one should tie off, between double ligatures, at least two 5-inch sections of small intestines, one just above the ileo-caecal valve and one taken from about the middle of the ileum. These portions of gut should be dropped into sterile salt mouth bottles, well stoppered and sent to a bacteriological laboratory as soon as possible. As the cholera spirilla, when associated with faecal bacteria, tend to die off within twelve to twenty-four hours it would probably be advisable to inoculate an agar or blood serum slant with material from the ileum at the same time the sections of gut are removed. For diagnosis of a cholera carrier with a normal stool or a cholera suspect with a diarrhoeal one inoculate 2 or 3 tubes of peptone solution with 2 or 3 loopfuls of material from the stool. With suspected carriers who are constipated and to whom one should not give purgatives we may insert into the rectum a rubber tube or a throat swab in order to obtain material immediately. The cholera spirilla grow rapidly and being strong aerobes, they grow on the surface of the fluid so that by taking a loopful from the surface, we may in three to eight hours obtain a pure culture. Should there be a pellicle present, this should be avoided in transfer by tilting the tube slightly, so that the material near the surface be obtained without touching the pellicle. Inoculate a second tube from the surface of this first and, if necessary, a third (enrichment method).
Smear the three-hour surface growth of a peptone culture on a dry agar surface in a Petri dish. From colonies developing make agglutination and, if desired, cultural tests. It is by immunity reactions and not by cultural ones that we identify cholera spirilla. The surface moisture of plates is best dried by the filter-paper top.
The cholera colony is easily distinguished from the ordinary faecal bacterial colonies by its transparent, bluish gray, delicate character.
A practical quick method is to make smears from suspicious colonies, stain for one minute with dilute carbol fuchsin and if vibrios are present to make 2 vaseline rings on a single slide allowing ample space at one end for handling the preparation safely. Inside of one ring deposit with a platinum loop a drop of salt solution and inside the ring nearest the end which is to be held by fingers or forceps deposit a loopful of 1 to 500 or 1 to 1000 dilution of cholera serum. The emulsion in the salt solution remains uniformly turbid and under a low power of the microscope (⅔-inch) shows a scintillating motility. The emulsion made into the drop of serum quickly shows a curdy agglutination and upon examination with the ⅔-inch objective shows clumping and absence of motility. Cover-glasses placed over the two vaseline rings assist in the study of the preparation.
The best-known selective medium for plating out cholera material is that of Dieudonne which is referred to under etiology. Apparently a more satisfactory medium is that proposed by Goldberger, this medium being transparent.
First prepare a 100% meat infusion by treating 500 grams of finely chopped lean beef with 500 cc. water and after three hours strain the infusion, adjust reaction to neutral with 5.3% anhydrous sodium carbonate, then add to each 100 cc. 2½ cc. of the 5.3% anhydrous sodium carbonate, sterilize in Arnold for one-half hour and filter. Next prepare a 3% meat extract agar and mix one volume of the alkaline meat infusion with 3 volumes of the hot melted 3% meat extract agar. Pour plates and cover with a piece of filter-paper and place in incubator for one-half hour until they are quite dry. The necessity for a surface without moisture applies to Dieudonne’s and Krumwiede’s alkaline egg media as well as this one. On this medium cholera grows well while faecal bacteria are restrained.
The cholera colony is clear, round and shows a brownish center but is without that striking bluish opalescence shown on ordinary agar plates.
While peptone solution is a more favorable enrichment medium and answers perfectly when cholera organisms are fairly abundant yet, when scarce, selective enrichment media may be desirable. Of these the best known is Ottolenghi’s alkaline bile. Goldberger prefers an alkaline egg peptone solution made as follows:
Shake up an egg with an equal quantity of water and add to this egg solution an equal quantity of a 5% solution of anhydrous sodium carbonate. Steam one hour. Then add 1 part of this alkaline egg medium to 9 parts of peptone solution, filter and sterilize. Recent reports on Aronson’s cholera medium would indicate its great value in stool examination for cholera. The organisms taken from such plates emulsify easily and there is no interference with their agglutinability. To prepare it add to 100 cc. of 3% nutrient agar, 6 cc. of 10% solution of exsiccated sodium carbonate and steam in Arnold sterilizer for fifteen minutes. Then add 5 cc. of 20% saccharose solution, 5 cc. of 20% dextrin solution, 0.4 cc. saturated alcoholic basic fuchsin and 2 cc. of 10% sodium sulphite. A precipitate forms which quickly settles and plates can be poured from the supernatant fluid. Cholera colonies develop in twelve hours and show as red colonies in fifteen to twenty hours.
Test for cholera red reaction. Add from three to five drops of concentrated chemically pure sulphuric acid to the first or second peptone culture after eighteen to twenty-four hours growth. Some specimens of peptone do not give the reaction. At times we only get the cholera red when we have a pure culture of cholera.
Prognosis
There is the greatest variation in the mortality in different epidemics as is true of most other epidemic diseases. At any rate 50% may be considered an average mortality.
Young children and old people give a very high mortality rate as is also true of alcoholics and those with kidney disease.
Prophylaxis and Treatment
Prophylaxis.—Of all the quarantinable diseases cholera is the one in which personal prophylaxis is apparently of greatest influence in protection from infection.
In the presence of cholera one should not only drink recently boiled water, which has been protected from the contaminating influence of flies, but all forms of uncooked food should be avoided. In the first rank of prohibited foods should be raw shell fish and uncooked salads. Such articles as lettuce and celery are particularly dangerous on account of the moisture retained. Fruits such as bananas and oranges can be made safe by covering them with boiling water for two or three minutes and subsequently peeling. Care must be taken that native servants do not put fish, which may have been contaminated with cholera-infected water, on the ice in an ice box and through such a source to have the butter, etc., infected. The most scrupulous attention should be given the matter of the care of the ice-box in the tropics.
If conditions are such that boiled water cannot be obtained the water may be treated with good quality chlorinated soda. As a stock solution we use 1 teaspoonful of chlorinated soda to 1 pint of water and of this 1 teaspoonful to 2 gallons of the water to be disinfected. Pottevin recommends six hours contact with hypochlorite of soda, 1 mg. per liter.
Besides care of the food and water ingested particular attention should be paid to the washing of the hands before eating and if in contact with cholera cases careful disinfection of the hands.
Experience in cholera epidemics has shown the importance of avoiding anything which might lower resistance. In particular are fatigue, excesses in alcohol or the taking of any kind of indigestible foods to be avoided. It must be remembered that the use of purgatives may set up cholera in a cholera carrier so that this possibility should be thought of.
Tea has been recommended as a prophylactic, as has also eucalyptus oil, 10 minims twice daily.
As acids have an inimical effect on the cholera spirilla some have recommended the use of acid drinks but as a matter of fact the best prophylactic is the normal gastric juice and there is a possibility that the use of such acid drinks might upset the digestion and thus defeat the object desired.
As to municipal measures for the control of a cholera outbreak the most important one is to diagnose cholera carriers, such cases often occurring in those associated with a cholera case. Such carriers should be isolated and their stools disinfected until at least 2 negative examinations show them to have ceased being cholera carriers. Of course a cholera case should be isolated and kept in a fly-screened room.
For disinfection of stools one requires an equal amount of a 5% compound cresol solution which when mixed with the same amount of stool becomes a 2½%[234] solution. This should be in contact with the stool at least one hour before emptying the container. Chlorinated lime, 1 pound to 4 gallons, makes a splendid disinfectant for stools—equal parts of this 1 to 16 chlorinated lime solution and stool.
Bed clothing or other material contaminated by vomitus or faeces should be immersed in a 2½% compound cresol solution. All food utensils should be disinfected by boiling.
Persons attending cholera cases should wear gowns and remove the same upon leaving the room. Particular care should be exercised in hand disinfection after attending a cholera case.
There is no danger from aerial conveyance of infectious material other than the possibility of one’s coming within the danger zone of a vomiting patient. Therefore, for disinfection of a room occupied by a cholera patient we need not use formaldehyde gas but washing of floors and lower part of walls with 2½% compound cresol solution is sufficient. The stock solution of chlorinated lime, 1 pound to 4 gallons, is suitable for mopping floors and walls.
Vaccination prophylaxis against cholera has been less used than has been the case with plague or typhoid fever. The anti-cholera sera have no practical value prophylactically and the same statement applies to the use of such sera in treatment of cholera.
Ferran, in 1885, was the first one to use cholera vaccines in prophylaxis. Haffkine, in 1893, adopted the use of a preliminary subcutaneous injection of an attenuated cholera organism to be succeeded later by one, the virulence of which had been exalted by passage through animals to a fixed virulence. (Pasteur’s anthrax method.) He now only uses the fixed virulence vaccine. This vaccine is not killed by heat.
The statistics indicate quite a reduction in susceptibility on the part of vaccinated persons (probably 8 to 1) but only slight lessening of mortality rate. Of 5549 nonvaccinated 198 contracted cholera and 124 died. Of 5778 vaccinated 27 contracted cholera and 14 died.
In the recent Balkan war (1913) Kolle’s vaccine was employed with considerable success. This vaccine is killed by exposure to 58°C. for one hour. It was found that this vaccine was not only of value prophylactically but diminished case mortality as well. With 91,224 persons vaccinated and 8,968 not vaccinated, the case rate among the inoculated was 0.7% and the death rate 10.2%, while among the noninoculated the case rate was 9.3% and the death rate 27.5%.
Ottolenghi prefers to sterilize with a temperature of 53°C. He gives 500 million at the first injection and 2 billion at the second.
Among 72,653 soldiers, having 2 inoculations of this vaccine, the incidence of cholera was about 13 times less than among 14,332 who were not vaccinated.
Of 2897 Greek sanitary corps men inoculated 0.45% were attacked while of 114,805 combatants, not inoculated, about 2% were attacked by cholera. One would naturally consider the greater exposure of the sanitary forces.
Cholera vaccines made from killed cultures are the ones now generally used.
During the World War a Roumanian regiment numbering 4,500 soldiers, had 386 cases of cholera develop in the course of six days, with 166 deaths. Vaccination[235] was commenced and during the interval between the first and second injections, new cases continued to appear. Two days after the second injection the epidemic ceased. In another regiment the commandant refused to have his men vaccinated. A group of Jewish soldiers, 200 in number, insisted on being vaccinated, which was done. Later the regiment was stricken by cholera and 450 cases developed. None of the vaccinated Jewish soldiers contracted the disease.
Some prefer sensitized living cultures for prophylaxis but such vaccines are less practical.
There is much to indicate that Strong’s cholera autolysate is of value prophylactically. In this cholera cultures are killed at 60°C. The killed culture is then allowed to digest itself in the incubator at 37°C. for three or four days (peptonization). The preparation is then filtered and from 2 to 5 cc. of the filtrate is injected.
Treatment.—Many of the older authorities recommended the use of various astringent medications for the checking of suspicious diarrhoeas and most of these prescriptions contained opium in some form, such as lead and opium pills or aromatic sulphuric acid and laudanum. In view of the fact that for the infection of animals Koch had to employ opium for checking peristalsis in addition to neutralization of gastric juice it would seem very undesirable to use opium by mouth. Calomel in divided doses and continued over one or two days, but not exceeding 7 or 8 grains, has been recommended.
At present the treatment which is thought to give the best results is the permanganate one proposed by Rogers. In this the patient is given calcium permanganate water ad libitum and 2-grain pills of potassium permanganate every half hour until the stools become more faecal in character. These pills are made up with vaseline and coated with a mixture of a 1 part salol and 5 parts of sandarach varnish.
Reports as to the use of kaolin in treatment and as a prophylactic have been favorable. The suspension in water is given as a drink and as an enema.
Rogers has recently been administering 1/100 of a grain of atropine sulphate morning and evening. His statistics would indicate a reduction in mortality of about one-half. Cases treated with atropine also rarely show collapse. Injections of adrenalin solutions have been recommended.
A great objection to any form of oral medication is the tendency to vomiting. This can in a measure be controlled by cracked ice or by a small hypodermic of morphia. The latter drug also relieves the very painful cramps.
One danger which must always be borne in mind in giving more than one dose of any drug subcutaneously is that with the slowing or cessation of circulation, coming on with the algid state, we have no absorption but, when the stage of reaction sets in and the drug, whether morphine or toxic stimulant, begins to be taken up, there may ensue a fatal poisoning.
However the views of authorities may conflict as to special forms of treatment, there is universal acceptance of the employment of intravenous injections of fluid to combat collapse. Normal saline is the fluid usually used, but Rogers recommends his hypertonic solution which[236] consists of 120 grains of sodium chloride, 6 grains of potassium chloride and 4 grains of calcium chloride to the pint of water.
In the Philippines the normal saline seemed to answer as well as the hypertonic solution.
Sellards had success in combating anuria, which is one of the most dangerous conditions encountered in cholera, and at the same time answered equally well with normal saline in relieving collapse, by giving 2% sodium bicarbonate injections.
There is a marked acidosis in cholera and this form of treatment seems indicated.
The objection to using sodium carbonate is that the salt has a lytic action on red cells in vitro and furthermore Sellards found that it tended to cause convulsions in one of his cholera cases. Sodium bicarbonate, even in 4 or 5% concentration, does not have any haemolysing effect on the red cells. Of course it is true that in sterilization the bicarbonate tends to be converted into carbonate but Sellards found that by sterilization in an autoclave connected with live steam, at 7 pounds pressure, this was minimized, only about 25% of the bicarbonate being converted into carbonate after 1 hour.
If the temperature by rectum is about normal or slightly below, the temperature of the fluid should be 102° to 104°F. and one usually gives about 2 quarts.
Owing to the collapse of the veins it is usually necessary to cut down on them instead of inserting the needle through the skin as for salvarsan injections. The same apparatus as for salvarsan injections is suitable but with a somewhat larger container as we give from 1 to 2 quarts of fluid. At least fifteen minutes should be taken up for the introduction of 1 quart of fluid.
To determine the necessity for intravenous infusion in cholera Rogers has recently recommended the employment of small bottles containing aqueous solution of glycerine with specific gravities varying from 1048 to 1070, increasing the specific gravity in each successive bottle by 2°.
Drops of blood from the cholera patient are deposited at the center of the surface of the fluid in the bottles from a capillary pipette. If the specific gravity of the blood is 1062 at least a liter of saline or sodium bicarbonate solution is needed. If 1066, at least 2 liters. Formerly he estimated the indications by blood pressure, considering a pressure of 80 in Europeans or of 70 in natives as indicating intravenous injections.
On the whole the reports from the use of anti-cholera sera are not very encouraging. Savas, however, was favorably impressed by such treatment during the Balkan war. It should be administered intravenously and early in the attack and given in doses of 50 cc. Of 61 severe cases, so treated, the mortality was 55.7%. Of 17 severe cases, not receiving serum treatment, all died.
Hot water bottles should be used to keep up the body heat. No food should be given during the first thirty-six hours but after that time we may give broths or albumin water.
CHAPTER XVI
MALTA FEVER
Definition and Synonyms
Definition.—Malta fever is a septicaemic condition due to the presence of the specific organism, Micrococcus melitensis, in the blood and various organs, especially spleen. It runs a protracted course, averaging three or four months, but is attended with very slight mortality (2%). Rare cases may run an acute course and show a high death rate. The fever course resembles that of a typhoid fever with two or more relapses, in that a step-like rise of fever for ten or twelve days is followed by a similar fall during the succeeding week or ten days, an afebrile interval of a few days then ensuing, to be followed by a second or third or even tenth febrile wave with the separating days of apyrexia. The course of the disease may last for a year or more attended with progressive anaemia and manifestations of neurasthenia. Very characteristic are sudden swellings of various joints which subside in a few hours to entirely disappear in a few days. Neuralgic manifestations, especially sciatica, are prominent features of the disease. It is chiefly spread by the milk of infected goats and can best be prevented by boiling such milk.
Synonyms.—Febris undulans (from the wave-like monthly accessions of fever). Mediterranean, Gibraltar or “Rock,” Neapolitan, Cyprus fever (from the geographical distribution). Febris sudoralis (from the night sweats). Mediterranean phthisis (from the bronchitis, anaemia and night sweats resembling phthisis). Melitensis septicaemia. Febris melitensis.
History and Geographical Distribution
History.—It is generally considered that a disease described by Hippocrates, in which there was an irregular febrile course without crisis but showing relapses and running a very prolonged course, was probably Malta fever.
In 1861 Marston showed on clinical and pathological grounds that the disease was different from typhoid fever.
In 1887, Colonel Bruce isolated the causative organism from the spleen at autopsy and established the demands of Koch’s postulates by reproducing the disease in monkeys with cultures from the spleen and then recovering the organism from the monkeys.
Our present accurate knowledge of the epidemiology of Malta fever and its connection with the use of the milk of goats is due to the work of a Commission appointed to investigate the disease—1904 to 1907.

Geographical Distribution.—It is usual to consider Malta as the focus of the disease, with the cities of the Mediterranean shores showing quite a degree of infection. It is probable that the spread of the disease has been in part connected with the importation of Maltese goats, these animals being desirable on account of their superior yield of milk. It is now known that outside of the Mediterranean basin the disease exists in India, East and South Africa as well as Northern Africa, China, North and South America and the West Indies.
Mohler has shown that the disease under the names of “slow fever” and “mountain fever” has existed in Texas and New Mexico for at least twenty-five years.
Etiology and Epidemiology
Etiology.—The causative organism, Micrococcus melitensis, is a small coccus, rather oval than round and about 0.4 micron in diameter. In morphology it is quite variable and may occur in pairs or in short chains and is Gram-negative. It emulsifies evenly and rapidly in a hanging-drop preparation and is nonmotile. Possibly on account of its showing a rather active Brownian motion there has been a reporting[239] of slight motility by some authorities. Very striking is the characteristic of very slow growth so that cultures on agar fail to show colonies before the fourth day.
These minute transparent colonies become somewhat opaque and about 1/10 inch in diameter by the tenth day. Gelatine is not liquefied and litmus milk is not altered. The optimum reaction of media is about +0.75 to phenolphthalein and it grows best at the body temperature. It has great powers of resistance to drying so that it survives in dust for long periods.
Horses, cows, asses, as well as goats, are susceptible. It is very difficult to infect rabbits, mice and guinea pigs. Monkeys have been chiefly utilized in experimental work.
It would appear as if there were other organisms closely related to M. melitensis and a great deal is now being written as to confusing serum reactions from the use of M. paramelitensis.
Evans and others have studied the relationship between Bacillus abortus and M. melitensis. Morphologically and culturally these organisms are quite similar and Evans has demonstrated a marked degree of cross-agglutination. This is a probable explanation of the finding by Kennedy of agglutinating power in the sera and milk of certain cows, but inability to isolate M. melitensis from the agglutinating milk.
Epidemiology.—Many experiments have failed to show any mosquito, biting fly or louse as a probable factor in the transmission of the disease. The infection is readily transmitted by subcutaneous inoculation so that in a case in goat or man, with the cocci in the peripheral circulation, it is reasonable to suppose that a biting insect might transfer the infection by going directly from one animal to another. There have been several laboratory infections, but when we consider that of the great number of cases treated at Haslar hospital and elsewhere in England, with frequent elimination of the organism in the urine, and practically no infections among the friends or attendants, it would seem as if usual methods of infection were inoperative. There does not seem to be a carrier problem in this disease. Urine showing bacterial contamination, when dried and mixed with dust, has caused infection and contaminated urine applied to the glans penis of a monkey caused the disease.
As a large proportion of the prostitutes of Malta showed infection and as M. melitensis was found in urine and vaginal discharges of many of these it is possible that sexual intercourse may be a factor in transmission.
The Commission noted many cases of Malta fever among the goatherds. By agglutination tests it was found that one-half of the goats showed agglutinins in their serum. Of 28 monkeys given infected milk 26 became infected. Very conclusive was the case of the “Joshua Nicholson,” which ship carried 65 Maltese goats from Malta to the United States. Of ten of the crew who drank goats’ milk on the voyage, eight became infected. Two who boiled the milk escaped infection. It is reported, that when the goats reached the United States and were quarantined, a woman drank of their milk and became infected.
What may be deemed proof positive is the practical disappearance of the disease among the naval and military forces of Malta, as the result of boiling the milk, while still continuing among native civilians. Bassett-Smith has noted that in 1905 there were 798 cases among civilians and 245 naval cases. In 1907 there were 457 cases among civilians and only 12 cases in the naval forces.
There are however occasional cases which Shaw has considered as due to carriers. As the organisms are excreted in faeces as well as in urine, and as the course of the disease is so protracted, as well as the convalescence, it would seem that the carrier factor should be of more importance than facts would justify.
Mohler has noted that in Texas, where the disease has existed for twenty-five years, the Mexican goatherds boiled their milk and hence were rarely infected.
Gentry and Ferenbaugh, in Texas, noted that cases of Malta fever were most common in the spring and early summer months when the goats were in full milk and the ranchmen were caring for the kids and teaching them to suckle. The disease in certain areas was called “goat fever” and in others “dust fever,” this latter name coming from the idea that the dust-filled goat pens had to do with the disease.
The souring of milk does not destroy the germs of the disease, hence transmission may be brought about by butter and cheese.
Malta fever was stamped out of Port Said by destroying all infected goats.
Infection may occur: (1) By the stomach atrium (usual); (2) contaminated dust reaching lungs; (3) by subcutaneous injection.
Pathology and Morbid Anatomy
The germs are found early in the blood and spleen; and are also present in lymphatic glands and kidneys.
The blood is most apt to contain them at the height of the fever curve and a striking feature is the appearance in waves of the organisms in blood, urine or milk. While serum immunity reactions are striking features, there is some question as to the conference of immunity by an attack.
At postmortem we have an enlarged, congested, soft spleen with swollen Malpighian bodies. The kidneys may show a nephritis and the mesenteric glands be swollen. The intestines fail to show the characteristic lesions of typhoid fever.
There may be evidences of myocarditis.
Symptomatology
A Typical Case.—Following a period of incubation, varying from ten to fifteen days, headache, malaise and anorexia set in with a step-like rise of fever from day to day.
The tongue is not heavily coated and is red at the tip and sides.
Constipation is the rule and there is an early tenderness and enlargement of the spleen. There is much to suggest typhoid fever in the gradual ascent of the remittent fever for about ten or twelve days and the gradual descent during the succeeding ten or twelve days, but the lack of apathy and slighter evidences of toxaemia differentiate. The patient is dejected rather than apathetic.
There is often a slight bronchitis, with cough, which, when associated with a profuse sweating at night, may suggest phthisis.

Following the initial period of fever there is usually a short afebrile interval of a few days to be succeeded by a second, third or many of these febrile waves, thereby making one of the names, undulant fever, appropriate. Anaemia becomes marked and cardiac weakness, as shown by palpitation and rapid, irregular pulse, apparent.
The symptoms which aid us most in diagnosis are joint manifestations and neuralgic pains. These may come on quite early in the course of the disease or be delayed until succeeding febrile waves set in. Swelling and pain, but without redness, of a single joint may come on rather suddenly, to have the acute symptoms subside in a few hours and to be entirely normal in three or four days.
Pains in the sacro-iliac region or pains resembling those of hypertrophic arthritis of the spine may be noted.
It is however the peripheral nerves, even more than the joints, for which the toxic effects of M. melitensis show a preference. The sciatic nerve seems to be most often involved and sciatica may set in suddenly and acutely, to pass off in two or three days, leaving a soreness over the course of the nerve and a tendency to recurrence. Orchitis may occasionally set in. There is usually albuminuria.
Insomnia is usually quite a prominent feature of the disease and there is a great tendency for nervous prostration to develop.
The usual course of the disease runs for three or four months but may last almost a year.
Other Clinical Types.—(1) The Malignant Form.—In such cases instead of the insidious onset we have the characteristics of a severe acute infection with high temperature from the beginning, ranging from 103° to 105°F. Such cases may show vomiting and early diarrhoea. This is followed by a typhoid state with cardiac manifestations in the way of irregularity of the pulse. An ordinary type of case may assume this malignant form and such cases may develop a broncho-pneumonia.
(2) The Intermittent Form of Hughes.—Here we have a type of case similar to the typical one but less severe. It is a subacute form which from time to time shows an intermitting fever. These cases may fail to show evidence of serious illness and the patient may continue his work although noting a progressive deterioration of health. Some very mild cases which only rarely show slight fever of a few days’ duration have been reported as ambulatory cases.
(3) The Disease in Infants.—Di Cristina and Maggiore have described various forms of the disease as observed in infants in Palermo. They note a hyperpyrexial type and an undulant type. A type with anaemia and marked cachexia is very severe. Another form shows cyanosis, irregular pulse and irregular respiration with marked sweats. Again the symptoms may be those of a cerebro-spinal meningitis.
Sequelae and Complications.—It should be borne in mind that while not serious from a standpoint of mortality this disease is to be dreaded by reason of the possibility of invalidism. The neuralgic pains, insomnia and mental depression render patients liable to the morphine habit. In pregnant women there is a tendency to abortion. In rare cases we may have intestinal haemorrhages with asthenic manifestations. Bassett-Smith has reported a case with extensive purpura. The same author in paramelitensis cases has noted the susceptibility to secondary streptococcal infections.
Symptoms in Detail
Temperature Chart.—Except in the malignant form of the disease, when the temperature may be rather continuous, the fever course is a step-like ascent with daily remissions for about ten days and then a similar descent. Following an evening rise of temperature night sweats may be noted.
It is the wave-like succession of such courses of fever, separated by afebrile intervals, that suggests the name undulant fever.
Circulatory System.—The disease shows rather a toxic effect on the heart as shown by palpitation and irregularity and rapidity of pulse rate.
In the beginning of the fever, however, the pulse rate is not very fast. Anaemia is a rather marked feature.
Respiratory System.—A slight bronchitis with cough tends to suggest phthisis in those cases which show rather marked night sweats.
Nervous System.—The organism seems to have a selective action on the nervous system as shown by headache, various neuralgias, insomnia, apathy and neurasthenia. Sciatica is probably the most common peripheral nerve involvement.
Joint Symptoms.—Very characteristic are the sudden and painful swellings of various joints, especially hip, shoulder, ankle and knee. Not rarely the costo-sternal articulations may be involved. The acute symptoms subside in a few hours and the joints become normal in a few days.
Alimentary Tract Symptoms.—The tongue may have a slight furring but the edges and tip are quite clean and red. Although anorexia exists with the fever the appetite tends to return with apyrexia. Constipation is usual. There is frequently tenderness of the epigastric region.
Genito-urinary System.—Other than for albuminuria and the presence at intervals of the causative bacteria in the urine, there is nothing of note, except the occurrence of orchitis in about 3 per cent. of cases.
The Blood.—The white count is about normal or slightly reduced—6500 on the average. The cells of lymphocyte type tend to show an increase in percentage with a corresponding reduction of polymorphonuclears.
There is a secondary anaemia.
The spleen shows early enlargement and tenderness.
Diagnosis
Clinical Diagnosis.—The diseases most apt to be confused with Malta fever are typhoid fever, malignant tertian malaria, liver abscess, influenza, phthisis and kala-azar.
Besides the agglutination, complement fixation or blood culture aids, we rely upon the sudden onset of joint involvement or neuralgic manifestations as indicating Malta fever.
Usually the splenic enlargement about corresponds with that of typhoid fever but at times it may be so marked as to equal that of malaria or even kala-azar.
The presence of rose spots as well as the marked apathetic state and the tendency to diarrhoea should aid in differentiating typhoid. Unfortunately for diagnosis the leucopenia and polynuclear percentage reduction is similar in the two diseases.
In kala-azar the double temperature rise in 24 hours with the Leishmania bodies in spleen puncture material, instead of M. melitensis, are differentiating.
The short course and more sudden onset of influenza and the more marked pulmonary symptoms of phthisis should prove diagnostic aids.
Liver abscess and empyema with their tendency to anaemia and sweating may prove confusing, but the history, leucocytosis and location[244] of pain should differentiate. Then too the joint and nerve manifestations of Malta fever are absent.
Laboratory Diagnosis.—Eyre obtained cultures from blood from the 2d to 300th day of the disease. He recommended the taking of at least 5 cc. from a vein and that this be done at a time when the fever is at its maximum point—the days when the fever is at its maximum and in the evening of that day. By taking 20 to 30 cc. in an equal amount of citrated salt solution, as described in chapter on blood examination, one should have as great success as had Eyre—158 positives in 235 cases or 65.4 per cent.
It must be remembered that the colonies only appear about the fourth day, becoming quite distinct by the tenth day.
Bassett-Smith takes about 10 cc. of blood in the afternoon during pyrexial waves and distributes this blood in several tubes of broth. He makes plates from these tubes every day. He also recommends the taking of 1 cc. of blood which he allows to clot and subsequently removes the serum and adds bouillon (clot culture).
Agglutination is the chief reliance in diagnosis. As result of two infections in his laboratory Widal uses emulsions killed by ¾% of formalin. He uses the microscopic method in the test with dilutions not exceeding 1 to 200. Such emulsions keep for at least a year.
In connection with agglutination tests Nicolle recommends that the serum be separated at once and removed from the clot and Nègre has shown that by heating the serum to 56°C., for thirty minutes, reactions are not obtained with nonspecific sera.
Some workers prefer the macroscopic agglutination.
Complement fixation methods are of value but the application of such tests is confined to large laboratories.
Prognosis
The mortality is usually reported as 2% but there have been epidemics where the mortality, owing to the frequency of the very fatal malignant type, has exceeded 10%. It must be remembered however that the invaliding connected with the long course of the disease and protracted convalescence makes Malta fever a serious affection. Neurasthenia, susceptibility to neuralgias, cardiac weakness and formation of morphine habit may result from the disease.
Prophylaxis and Treatment
Prophylaxis.—The danger from carriers seems slight but should be considered.
Disinfection of excreta, in particular urine, is important.
Boiling of goat’s milk or killing of infected goats is a prime consideration.
A rapid method of detecting infected goats is by carrying out a macroscopic agglutination of M. melitensis with the milk obtained from goats. The lacto-reaction should be confirmed by a serum one.
Treatment.—There is no specific treatment generally recognized as efficient. Recently, an anti-melitensis serum, from animals injected with the nucleo-proteid material from the organisms, has been used with some success.
A serum prepared by injecting horses intravenously with the specific organism has been recommended by Sergent in doses of 50 cc.
Bassett-Smith recommends an autogenous vaccine, during the afebrile period, in doses of from 50 to 200 millions. He thinks that the best results are obtained with sensitized vaccines. During acute phases the vaccine treatment is detrimental—it is only in chronic cases that such treatment is of value. Some prefer to give doses of 10 million or so at short intervals. He also thinks yeast in 2-dram doses to be of value. Phenacetin or aspirin may be given, but the heart weakness makes extensive use of these analgesics dangerous.
The diet should be that for any acute disease but the protracted course makes it necessary to have regard to an adequate food value. Care should be taken to avoid chilling or fatigue.
Some recommend moderate use of alcoholic stimulation but this treatment is questionable.
Cold sponging and local applications to joint or nerve involvements are indicated.
Morphine should be employed with great caution.
CHAPTER XVII
LEPROSY
Definition and Synonyms
Definition.—Leprosy is a very chronic, almost incurable disease, with a protracted period of incubation (two to ten years), which sets in with indefinite prodromata of malaise, and irregular febrile attacks associated with sweating and somnolence. In nerve leprosy there may be vague manifestations of neuritis as prodromata. There are two well-recognized types of the disease. The type characterized by granulomatous proliferations in corium and subcutaneous tissues, as well as lymphatic glands, is known as nodular or skin leprosy. It shows spots and nodular infiltrations, chiefly about lobes of ears, alae of nose and region of eyebrows, with falling out of hairs of eyebrows and bearded region, and also involves extensor surfaces of forearms, dorsal surfaces of hands and feet. The palms of hands and soles of feet are almost never invaded. The other type is known as nerve or maculo-anaesthetic leprosy and is characterized by nerve thickenings, flat anaesthetic spots, chiefly of the covered region of the body, muscular palsies and atrophies, with trophic changes leading to contractures and mutilations. When the two types are associated we have mixed leprosy.
The disease is caused by an acid-fast bacillus, which has not surely been cultivated or inoculated into animals with pathogenic result, and which is found in extraordinary abundance in the granulomatous subepithelial tissues of nodular leprosy and in scanty numbers or not at all in the perineurium and endoneurium of the ulnar, facial or perineal nerves.
Synonyms.—Lepra. Elephantiasis Graecorum. Leontiasis. Satyriasis. French: La Lèpre. German: Aussatz.
History and Geographical Distribution
History.—There are those who consider India as the home of leprosy, a condition corresponding to the disease having been described in the Rig Veda, of date of 1400, B. C.
Others regard Egypt as the original focus, a disease similar to leprosy having been described in the “Ebers papyrus” of date of about 1300, B. C.
Any one reading chapter xiii, Leviticus, must be convinced that the disease there described as leprosy was of a different nature. We find statements to the effect that where the hair in the spot is white and the spot deeper than the skin of the flesh that it is leprosy; again, if there be a white or red rising it is not leprosy, but if lower than the skin it is leprosy.
According to Unna the term Zaarath had a theological rather than a medical meaning. At the same time other references in the Bible would indicate that leprosy was more or less prevalent among the Jews of that period.
It is very probable that the ancients confused leprosy with many other diseases where ulceration and nodular disfigurement were conspicuous features.
From the fact that leprosy was called the Phoenecian disease it would seem that Asia was the real home of the disease.

It is well established that leprosy was introduced into Europe, from Egypt, in the first century, B. C., by the returning legions of Pompey.
As a result of the crusades, leprosy was spread widely over Europe by the crusaders, so that in the 14th century the disease was so prevalent, that it required approximately 20,000 leper asylums to care for the lepers. In France alone there were about 2000 such leprosaria.
As a result of the most drastic measures of isolation the disease began to decrease in the 14th century and had practically disappeared from Europe, as a whole, by the 15th century.
Geographical Distribution.—With the exception of a limited and steadily diminishing number of cases in Norway and Sweden, with an uncertain number in the Balkan region and Turkey, leprosy has almost disappeared from Europe. Parts of Brittany and Provence in France show cases and there are a considerable number in Portugal and Spain.
Africa is heavily infected with the disease, especially in Central and East Africa. In certain portions of the Cameroons (Banyang) it is so common that one in every four persons suffers from leprosy.
Asia has many important leprosy centers, there being a very great number in China and India. There are about 100,000 lepers in Japan and about 3000 in the Philippines.
In 1902 there were 278 lepers in the United States, of which number 145 were native born. In 1912 there were only 146 distributed chiefly in three centers: (1) That of the Great Lakes, there being now 13 cases in Minnesota as against 27 in 1900; (2) among the Orientals of the Pacific Coast, and (3) in the Gulf region, especially about Louisiana and Florida.
There are 696 lepers in Hawaii and 28 in Porto Rico.
In South America, the disease is found in Columbia, Venezuela and Brazil as is also true of Mexico and Central America.
In Australia the disease is found in Queensland and New South Wales.
It also prevails in New Caledonia and the islands of the Pacific.
Etiology and Epidemiology
Etiology.—Leprosy is caused by an acid-fast bacillus, Bacillus leprae, which rather closely resembles the tubercle bacillus morphologically as well as tinctorially. It was first discovered by Hansen in 1871 and fully reported in 1874. Much of our knowledge of its characteristics is due to Neisser (1879).
The leprosy bacilli are found in profusion in the granulomatous tissue of the corium and subcutaneous structures of the leprous nodules, chiefly within cells called “lepra cells” and also within endothelial and connective-tissue cells as well as lying free, packed in lymphatic channels, the so-called “globi.”
The leprosy bacillus may be distinguished from the tubercle bacillus by the following points:
1. The presence ordinarily of huge numbers of bacilli often grouped in packets like a bundle of cigars tied together.
It will be remembered that it is very difficult to find even a single tubercle bacillus in a skin lesion. Leprosy bacilli form palisade groups but not chains.
2. The leprosy bacilli stain more solidly and when granules are present they are coarser and more widely separated than the fine granulations of the tubercle bacillus.
3. They do not stand decolorization quite as well as the tubercle bacillus. With 20% sulphuric acid in water they hold their color almost as well as tubercle bacilli but with 3% HCl in alcohol they decolorize in about two hours as against twelve to twenty-four hours for the tubercle bacillus.
4. Leprosy bacilli have neither been surely cultivated nor surely inoculated with pathogenic results into guinea pigs or other experimental animals and it is by the negative results upon cultivating or animal inoculation that we have our surest method of differentiation from tubercle bacilli.
Leprosy bacilli are chiefly spread through the lymphatics, but in nodular leprosy, their occurrence in the blood stream during the febrile accessions is so constant that this route may also be of importance. Next to the corium they are most abundant in the lymphatic glands. They stain readily by Gram’s method.
A great amount of work has been done within recent years in attempting to cultivate the leprosy bacillus.
In 1900 Kedrowsky culturing material from 3 cases of leprosy obtained diphtheroids from two and a streptothrix from one. A rabbit was inoculated first intracerebrally and later intraperitoneally with this nonacid-fast streptothrix and, when killed six months later, showed peritoneal nodules, from which both diphtheroids and acid-fast bacilli, but not a streptothrix, were recovered culturally. Injections of cultures of the acid-fast bacilli and diphtheroids into rabbits and mice produced nodules which when cultured showed acid-fast organisms or diphtheroids.
In 1901 he cultivated a diphtheroid from a fourth case of leprosy.
Fraser and Fletcher working with Kedrowsky’s culture produced peritoneal nodules with the killed as well as the living organism. They were able to produce the same results with B. phlei. With emulsions of leprous nodules, rich in leprosy bacilli, they could not produce similar lesions in the experimental guinea pigs.
Rost obtained a culture on a salt-free medium from which he prepared his leprolin by a process similar to that used for old tuberculin. It was claimed that leprolin had marked curative power in leprosy. Recently Williams and Rost have cultivated a streptothrix on a medium containing milk.
Clegg, by inoculating his medium with cultural amoebae, obtained growth of a diphtheroid organism, with acid-fast tendencies, from the spleen pulp of lepers.
Duval, by using media containing amino-acids, as result of tryptic digestion, brought forward two organisms, one of which was a diphtheroid and grew luxuriantly while the other showed a slow scanty growth and was acid-fast.
Bayon, by using placental media, isolated an organism rather resembling that of Kedrowsky. These organisms alone responded to immunity tests when such were made by Bayon and they alone gave rise to tissue changes resembling those of leprosy when injected into animals.
Professor Deycke obtained a streptothrix-like growth from the granulomatous tissue of excised leprous nodules. The ethereal extract from this culture gave a neutral fat which he called nastin and which is the basis of a leprosy treatment.
Quite recently and after working for eighteen months, with material from 32 nonulcerative cases of nodular leprosy, not only with media as recommended by Duval, Rost and Bayon, but with blood and serum culture media, both by aerobic and anaerobic procedures, Fraser has been unable, in a single instance, to obtain any evidence of growth from this wealth of leprosy material.
As being opposed to the possibility of culturing the human leprosy bacillus, it may be stated that most of the experiments along this line with rat leprosy, a disease occurring naturally in rats and caused by an organism almost identical, as to lesions produced, with the leprosy bacillus, have been negative. Bayon, however, states that he has cultivated the bacillus of rat leprosy.
Epidemiology.—There is a consensus of opinion that every case of leprosy owes its origin to contact, direct or indirect, with some other[250] case, but evidence as to the manner in which the disease is transmitted, or even the proof of transmission, is to a great extent lacking.
Every book refers to the inoculation experiment by Arning, of a freshly excised leprous nodule sewn into a skin incision of the arm of a condemned criminal. In this case a neuritis developed shortly after the inoculation and the patient showed fully developed leprosy three years later. Unfortunately for the value of the experiment the man was a native of Hawaii and had lepers in his own family. Against this experiment are the numerous instances where physicians have inoculated themselves and others with leprous material with invariably negative results.
Danielson inoculated himself and nine others with leprous material and later Profeta repeated the same, but without success in a single instance.
As regards those living for a long time in attendance on lepers there have been a very few instances of the contraction of leprosy as in the case of Father Damien at Molokai, and two instances in Sisters of Mercy. Such cases however are most exceptional, as the hundreds of attendants on the unfortunates continue their work for years without showing any signs of leprosy.
It is stated that there has never been an instance of transmission of leprosy to any attendant at the Saint Louis Hospital, Paris.
There are two cases which show that those who live in close relation to lepers may develop the disease; in one, a leper returned to Ireland and his brother, who had never been in a leprosy country, but who had occupied the same bed with the leper and worn his clothes, developed the disease in about five years. A similar case is reported from Germany.
As showing that even with intimate contact, infection is rare, it is stated that of 225 healthy Hawaiians, living in the same houses with lepers, only 4½% contracted leprosy. Even when married to lepers only 9 out of 181 healthy people contracted leprosy from their leprous mates.
In Japan, 7% of children of lepers contract the disease, 3.8% of those married to lepers and 2.7% of people living in the same house with lepers.
Just as with tuberculosis, in which all evidence points to the predominance of infection in early life and its infrequency in adult life, so does it seem to be true of leprosy. Among 10,000 lepers in the Culion leper colony, Denny notes that 35% were brothers and sisters, 27% were cousins, 11% were children of lepers, 7% parents of lepers, and only 1% husband and wife. This would indicate that the relationships involving intimate contact in childhood are etiologically most important.
One of the strongest proofs that leprosy is at least feebly contagious is that based on the disappearance of the disease following isolation[251] of the lepers. The best instance is that of Europe, in the thirteenth and fourteenth centuries, where, with 20,000 leper asylums for isolation, the disease disappeared by the fifteenth century. In Norway, there were 2833 cases in 1856, while in 1907, there were only 438 left.
At the end of 1913 there were only 285 cases, 181 of these being interned and 104 in their own homes. The reduction is attributed to isolation.
This might have occurred without isolation because Hansen in investigating the descendants of 160 known Norwegian lepers, who immigrated to the North-western States of America, was unable to find trace of a single leper among their descendants.
This and other facts militate against the views that leprosy may be inherited and the idea is generally held that if a child be taken away from its leprous surroundings after birth there is little or no likelihood of its developing leprosy.
Again, it is a well-recognized fact that leprosy is more than twice as common among men than among women. It is probable that the greater opportunity for contact with lepers by man is the explanation of the greater frequency.
Views as to Mode of Transmission.—It may be stated that nothing definite is known. There has been an idea that itch mites might transmit the disease but no proof has been advanced. Lebouf found leprosy bacilli in the stomachs of flies, which had been feeding on leprotic ulcerations, and did not find acid-fast rods in flies which had fed on persons with nerve leprosy or upon those not showing open lesions. He thinks that flies may deposit faeces containing bacilli about the nasal orifices or upon wounds of well persons, bringing about thereby their infection.
Skelton was unable to find evidences of leprosy bacilli in bedbugs living in the beds of lepers. Paldrock also was unable to find any evidence of leprosy bacilli in bedbugs a few hours after feeding on leprous tissue, but did find acid-fast rods in cockroaches which had fed on leprosy nodules, even fourteen days after the feeding.
A. J. Smith fed bedbugs on Duval’s organism and recovered acid-fast bacilli for considerable periods. The question arises, however, as to the significance of Duval’s bacillus for leprosy.
Acid-fast bacilli have been reported from head lice and mosquitoes, when the insects have been feeding on leprous tissue, but little or no evidence of any multiplication has been obtained.
For many years Jonathan Hutchinson insisted that leprosy was caused by the eating of imperfectly cured or decomposing fish, a view which now has no supporters.
For a time it was considered that the initial lesions of leprosy were to be found in the nasal mucosa and especially in ulcerations of the nasal septum and that it was by the atrium of the nasal mucous membrane that infection occurred.
There is no question but that the examination of the nasal mucus for leprosy bacilli is of prime importance in diagnosis and it may be that cases showing ulcerations of the septum are especially dangerous when sneezing, but very few believe that leprosy is to any extent contracted through this channel. De Azevedo examined smears from the nasal mucosa in 59 persons who were in close contact with lepers without finding acid-fast bacilli in a single instance.
With a period of incubation covering from two to ten years it is of course manifestly difficult to arrive at any correct idea as to transmission but there is a growing belief that the free and frequent use of soap is a decided factor in preventing infection which may, like rat leprosy, be best brought about by continued contact with a skin surface more or less abraded. There has been a suspicion, but no proof, that sexual intercourse may bring about infection.
Rat Leprosy.—A disease occurring naturally among rats was first observed by Stefansky, in Odessa, in 1903.
There are two types: (1) Of skin and muscles, and (2) of the lymphatic glands. In the skin form areas of alopecia are present with thickening of the site invaded. These areas are most often on the back of the head. Just as in human leprosy the epithelium is unaffected, the corium however being filled with cells packed with acid-fast bacilli, exactly similar to the picture in human leprosy. Ulceration of these subcutaneous nodules is common.
In the glandular type the glands are enlarged and the lymph sinuses packed with the causative bacilli.
In rat leprosy it has been found that infection of other rats takes places as readily through slight abrasions of the skin as when material is injected subcutaneously.
The idea is that natural infection occurs by way of the skin and through the lymphatics. There is no evidence that insects play a part in transmission.
Rat leprosy prevails extensively in Europe, Asia and America. Although similar etiologically and pathologically there does not seem to be any connection between the disease in rat and in man, as is the case with human and rat plague.
The prevalence of rat leprosy in the various parts of the world varies greatly; thus in Odessa 4 to 5% of the rats are infected while in San Francisco only ⅕ of 1%.
Pathology and Morbid Anatomy
In whatever way introduced the leprosy bacilli tend to invade and multiply in the lymphatics of the corium and subcutaneous tissues. In response to irritation, cells of disputed type, possibly plasma cells, appear and phagocytize the bacilli in large numbers, so that eventually the outline of the cell, as brought out in acid-fast staining, is that of a mass of red bacilli.
These red-staining bodies are called lepra cells. In addition, endothelial cells phagocytize the bacilli and these with their bacilli, together with the free lying masses of bacilli in the lymphatic sinuses, make the so-called “globi” when seen in transverse section. The toxicity of the lepra bacillus is only slight so that we may have very large giant cells of the Langhans type and this probably explains the absence of caseation in leprosy. The arteries of the leproma, as the granulomatous mass is termed, undergo an arteritis with thickening of their walls.

The leproma is a mass of cells of varying sizes and types in a connective-tissue framework. The infiltrations are chiefly about the hair bulbs, sweat glands and arteries. The epidermis is separated from the leproma by a connective-tissue layer and is uninvolved except for a thinning out of the layer and obliteration of the interpapillary epithelial pegs.
Incision of a leprous nodule shows a smooth glistening cut of a yellowish to slate gray color.
In nerve leprosy the cellular proliferations in the region of the blood vessels and later in the perineurium and endoneurium cause pressure on the axis-cylinder with consequent degeneration. The affected nerves are swollen and reddish-gray in color. It is now thought that an[254] axonal degeneration involves the cells of the anterior horns so that this, as well as the peripheral neuritis, is a factor in the muscular atrophies which are features of the disease. The sensory fibres are destroyed before the motor ones.
Leprous changes are common in the anterior part of the eye, as of conjunctiva, cornea and iris, but rare in the posterior eyeball. The mucosa of tongue, larynx and, pharynx is often involved. Cartilage and bone are destroyed through pressure of the granulomatous tissue.
The ovaries and testes may show connective-tissue increase.
Nephritis is rather common in leprosy but there is considerable doubt whether the lungs are invaded by leprosy, except most rarely.
Next to skin, mucous membrane and nerves, the lymphatic glands show the greatest involvement.
The liver not uncommonly in nodular leprosy and more rarely the spleen may show connective tissue or cellular infiltrations.
Symptomatology
The period of incubation of leprosy is peculiarly prolonged and is at any rate from two to five years and may extend over many years, Hallopeau having recorded a case where the disease did not develop for twenty-seven years after the patient left the infected district. The early manifestations are vague and indefinite, consisting chiefly of malaise, weariness and mental depression.
There are often noted (a) irregular accessions of fever (leprotic fever), attended with rather profuse sweating, so that the onset may be mistaken for a malarial infection; (b) progressive weakness, the patient being easily fatigued with a tendency to somnolence; (c) alternating attacks of dryness and hypersecretion of the nasal mucous membrane, with frequent attacks of epistaxis, and (d) various neuralgic manifestations or paraesthesias as well as headache. These prodromal manifestations usually precede but may accompany the outbreak of the spots.
It is the prominence of the nasal manifestations that has caused Sticker to insist that the primary lesion of leprosy is of the nasal mucosa, the general view, however, being that this view is without sufficient foundation and as a matter of fact some have recently suggested that the disease first manifests itself in the lymphatic glands, punctures of such structures showing bacilli rather frequently, although in less proportion than upon examination of the nasal mucosa.
All authorities recognize two well-separated clinical types of leprosy, one the nodular, skin, hypertrophic or tubercular form and the other the smooth, nerve, maculo-anaesthetic or atrophic form.
These fairly distinct types tend to run into one another and in such cases we have the mixed form of the disease.
Following Manson I use the terms nodular and nerve leprosy. It is usually stated that in Northern climates nodular leprosy forms about 70% of cases while, in the tropics, the larger proportion is made up of nerve leprosy.
At one time a classification of the 239 lepers at San Lazaro Hospital, Manila, P. I., showed 97 cases of nodular, 42 of nerve and 93 of mixed leprosy, with two cases of doubtful nature.
Nodular Leprosy
A Typical Case.—After more or less indefinite and uncharacteristic prodromata the definite onset is by an outbreak of brownish red spots which later become pigmented and thickened. These spots are at first erythematous and tend to come out in crops, attended with attacks of irregular fever. They soon have the appearance of limited areas of sunburn. They vary in size from 1 or 2 millimeters to a blotch the size of the palm of the hand.
They are raised and have a preference for appearing on the lobes of the ears, the nasal alae, the forehead, eyebrows, cheeks and chin.
The extensor surfaces of the forearms, thighs and buttocks are also favorite sites for the indurated spots. The palms of the hands, soles of the feet, hairy scalp, groin and axillary regions are almost never attacked.
These spots may be hyperaesthetic at first but soon show loss of pain and temperature sense with retention of touch sensation (dissociation of sensation). These spots do not sweat, they remain dry even in a general perspiration.
Following successive febrile accessions and reappearances of spots we have developed reddish-brown nodular masses, usually on the sites of the spots.
When the nodules are grasped between the fingers one usually finds them elastic to touch. As the result of active sebaceous secretion these nodules have a greasy appearance.
These protruding nodules may give the face a leonine appearance, hence the name leontiasis, or that of a satyr, hence satyriasis. With the development of the nodules the hair falls out of the eyebrows and bearded face. Nodules develop in the mucous membranes of the nose, mouth and larynx, giving rise to foetid discharges and obstruction of the nares, difficulty in mastication as well as in breathing and a raucous voice.
The eye is involved with frightful frequency in this form of leprosy, there being infiltrations of the eyelids, conjunctivae, cornea and iris, with subsequent ulcerations and loss of sight.
The nodules on face, backs of hands, buttocks, etc., may disappear by resolution but the tendency is for them to ulcerate and produce various contractions and deformities.

The glands in the region of the lesions become enlarged but do not tend to suppurate.
Visceral involvements are not common but serious lesions of the liver have been reported.
The course of the disease is essentially chronic and if some intercurrent affection does not carry off the patient, the end comes in a cachexia in about ten years, the temperature gradually falling and a state of somnolence ushering in the end.
When nerve leprosy sets in upon a nodular type the life of the patient seems to be prolonged.
Nerve Leprosy
A Typical Case.—The prodromal manifestations are characterized by the results of irritation of the granulomatous tissue upon the nerve fibers and are chiefly neuralgic pains or signs of sensory disturbances as formication, paraesthesias, etc. In particular, are the ulnar, peroneal and facial nerves attacked, the process very rarely extending above the knee or elbow.

Anaesthesia of the region supplied by the ulnar nerve with contractures of the fourth and fifth fingers may be signs directing our attention to the true nature of the disease and in those cases where the appearance of smooth yellowish-brown spots precedes the neuritis manifestations we may here also find anaesthesia, provided the eruption has lasted for some time.
In brief the fully developed case of nerve leprosy shows anaesthetic spots, trophic lesions of the skin and bone, together with muscular palsies. The spots often appear singly and may be from ½ to several inches in diameter. They are not raised, have a sunburnt color and do not sweat. Instead of having a preference for the exposed parts they most frequently appear on the covered portion of the body or limbs as trunk, buttocks, scapular region, thighs or arms, although the first appearance of spots may be on the face.

These spots often look like ringworm lesions, as they have an erythematous border with a paler center, but they are oval in outline rather than round and there is no scaling. Bullous eruptions, which are most frequently noted about the knuckles, are rare manifestations of nerve leprosy. They are often followed by ulceration.

About this time the nerve trunks begin to enlarge, especially the ulnar at the elbow and the great auricular as it crosses the sterno-mastoid muscle. The characteristic nerve enlargement is spindle-shaped or beaded.
These nerve enlargements are at first tender but later become painless and we have extensive areas of anaesthesia and trophic changes of the skin and nails of[260] fingers and toes such as felons, glazed skin, bullae, which latter on rupturing leave ulcers.
We also have absorption of the bones of the phalanges.
The phalangeal bones may be completely absorbed and a distorted nail cap the end of the metacarpal bone (lepra mutilans). Owing to the anaesthesia lepers often burn or injure their fingers and toes. Perforating ulcers are more common in leprosy than tabes.
Muscular palsies, atrophies and contractures are more common in the face and upper extremity than in the lower extremity. We may have changes quite similar to those of progressive muscular atrophy, the thenar and hypothenar, as well as the interossei, undergoing atrophy and resulting in the claw hand. There is extension of the first joint and flexion of the two distal joints of the fingers. Such hands may function quite well. Wrist-drop is not uncommon but foot-drop is rare. Rarely Charcot’s joint condition may be observed.
Of the facial muscles the orbicularis palpebrarum is most apt to show paralysis. The eyes are affected much less frequently in nerve leprosy than nodular, 45% as against 85% for nodular leprosy. The most common changes in nerve leprosy are ectropion of the lower lid and subsequent corneal ulceration.
Mixed Leprosy.—In mixed leprosy we simply have a combination of the manifestations of the two main types and as a matter of fact the majority of cases tend eventually to assume a mixed type.
Symptoms in Detail
Temperature Course.—On the whole leprosy runs an afebrile course except for the accessions of irregular fever at the time of the appearance of the successive crops of spots. This leprotic fever lasts for a few days or a week or so and then the course becomes afebrile. At such times sweating may be present and suggest malaria. In the final stages of leprosy the patient may run a high fever for long periods, associated with profuse sweating and loss of weight.
Skin.—The raised spots of nodular leprosy tend to come out in numbers on lobes of ears, over eyebrows and on cheeks, as well as backs of hands and forearms and on buttocks and feet. Soles of feet and palms of hands almost never show spots. In nerve leprosy the spots are often single and flat and often appear on parts of body covered by the clothing, as trunk, thighs or arms. The spots of leprosy are anaesthetic, often showing dissociation of sensation. The indurated spots of nodular leprosy are succeeded by tubercle-like growths. The hair falls out of the areas occupied by the spots.
Mucous Membranes.—The nasal mucosa is in particular studded with nodules which later undergo ulceration. An ulcer of the septum is often the first place from which leprosy bacilli may be obtained. The pharynx and larynx are also involved early.
Nervous System.—Besides the characteristic anaesthesia we have various manifestations of neuritis, especially involving the ulnar, facial and peroneal nerves. The affected nerves show a fusiform enlargement and are tender. Later we have trophic changes in skin, bone and nails of the fingers and toes. Absorption of bones and perforating ulcers are common. Muscle palsies and atrophies, especially the main-en-griffe, are common. The orbicularis palpebrarum is not infrequently paralyzed. The olfactory, optic and auditory nerves are rarely if ever involved. The reflexes are slightly exaggerated.
Patients often complain of a sensation of cold. Some authorities have called attention to the frequency of a mental and moral apathy in lepers.
The Circulatory System.—Honeij considers a high pulse rate, especially in the morning, as characteristic of progressive stages of leprosy.
The Eye.—In nodular leprosy eye lesions, chiefly leprotic nodules in conjunctivae or iris, with subsequent ulceration, are met with at some time in the course of the disease in almost 90% of cases. In nerve leprosy, corneal ulcerations, chiefly resulting from paralyses of the facial muscles, with ectropion, give eye symptoms in about 45% of cases.
Genito-urinary Symptoms.—Atrophy of the testicles with increase of connective tissue often result in males but data would indicate that the procreative power of the female is but little diminished. Lepers often die of renal complications, the kidney lesions being rather those of amyloid change. Bacilli may be eliminated in the urine during accessions of fever.
The Lymphatic Glands.—These tend to enlarge and show bacilli, but rarely suppurate.
The inguinal and cervical glands are most often enlarged.
The Blood.—The changes, other than those of a secondary anaemia as the disease progresses, are not characteristic. Bacilli are present in the blood of cases of nodular leprosy quite constantly but less so in that of cases of nerve leprosy. The bacilli are more apt to be found in the blood at the time of febrile accessions.
Diagnosis
Clinical Diagnosis.—It must be remembered that leprosy is very slow in development, so that for months or even years there may be but slight indications of the disease, as an anaesthetic spot or the palsy of an orbicularis palpebrarum. One should always run over the lobes of the ears or region of the eyebrows to feel for shot-like nodules.
In the making of a diagnosis the information as to possible exposure to the disease is of first importance.
The leprous spots are at first rather oily from increased action of the sebaceous glands but subsequently become dry. In ancient times the hypersecretion of sebaceous material about the facial spots of nodular leprosy served as the basis of a test for leprosy, the suspected eruption being dashed with water. If the surface was not wetted it was a point in favor of leprosy. Of prime importance however is the pin prick for anaesthesia, which is the most important distinguishing characteristic,[262] next to the finding of the bacilli, for a leprous spot. The anaesthesia is more marked in the center of the spot and may show dissociation of sensation. It is very important to examine for enlargement of the ulnar or great auricular and the earliest signs of a nerve leprosy may be anaesthesia and a slight contraction of the ring and little finger.
Of the general diseases, which may be confused with leprosy, we have the circumscribed form of scleroderma. Such spots however are dead white in color and are not anaesthetic. The prodromal manifestations with fever and sweatings simulate malaria. Elephantiasis and Madura foot have been confused with leprosy but the marked tendency to limitation to the lower extremities and absence of anaesthesia should differentiate. Probably the most difficult disease to differentiate from leprosy is syringomyelia. Morvan’s disease is only a form of syringomyelia in which the neuralgic pains, anaesthesia of the skin and painless whitlows, with tissue loss, are features. In fact Zambaco has advanced the idea that Morvan’s disease is leprosy.
In syringomyelia the dissociation of sensation is marked, as with leprosy. In syringomyelia, however, the upper extremities are, as a rule, alone affected and the muscular atrophy is more of the scapulohumeral type, with involvement of trunk muscles causing scoliosis, than of the thenar and hypothenar eminences, so that while the fingers may be more contracted and rigid than in leprosy we do not get the main-en-griffe. The anaesthetic areas of syringomyelia continue to sweat, and we may also get spastic symptoms and speech defects in syringomyelia.
Raynaud’s disease has also been confused with leprosy.
Of the skin diseases the most important confusing lesions are the cutaneous manifestations of tuberculosis and syphilis. In lupus the tubercles are very much smaller, show the apple jelly appearance, the lesion spreads peripherally, is rather purplish and is not anaesthetic. Syphilitic ulcerations are more punched out, do not affect the same sites and respond to syphilitic treatment immediately. You do not find nerve enlargements in syphilis.
There is great lack of agreement as to the frequency of the Wassermann reaction in leprosy, some reporting a positive test as common in nodular leprosy while others have reported negative findings where there was not ground for suspecting syphilis. Nerve leprosy does not often give a positive test.
Fletcher obtained 22% positives in 100 cases of leprosy—28% in nodular and 17% in nerve cases. One-third of the cases gave a history of syphilis.
Sutherland and Mitra obtained 17 positive Wassermann reactions in 34 nodular cases, 16 positives in 52 anaesthetic cases and 8 positives in 14 cases of mixed leprosy. The sera of 12 children of leprous parents were negative.
The luetin reaction is negative in leprosy.
Mycosis fungoides has not the characteristic location about the face and itches markedly and does not show anaesthesia.
Vitiligo shows an abrupt margin and is not anaesthetic.
Laboratory Diagnosis.—The usual procedure is to scrape a spot or nodule with a scalpel until the epidermis has been gone through and then smear out the serous exudate on a slide and stain by the Ziehl-Neelsen acid-fast method or by Gram’s stain. Twenty per cent. sulphuric acid is less apt to decolorize than the 3% acid alcohol, the leprosy bacilli being less resistant to acid alcohol decolorization than to aqueous acid solutions. There is a great variation in the resistance to decolorization of leprosy bacilli, a preparation from one case holding its color almost as well as tubercle bacilli, while material from another case may decolorize very easily.
I am partial to Tschernogabow’s technique. In this, one punctures the subepithelial granulomatous tissue with a capillary pipette, the end of which has been broken off by tapping the point in order to give a cutting point, and the serum which exudes is smeared out and stained.
Some prefer emulsifying a piece of the tissue and centrifuging and staining the sediment. Quite recently the antiformin method of treating leprous tissue, as for tuberculous tissue, has been used.
Many insist that the best method is to cut out small sections of the lesion, going well into normal tissue, and putting through paraffin and cutting thin sections and staining. Gram’s method, counterstaining with bismarck brown, gives beautiful preparations. For acid-fast staining first stain with haematoxylin to obtain a histological background and then steam with carbol fuchsin, decolorize very briefly with acid alcohol, then through absolute alcohol and xylol.
Of the greatest diagnostic value is the staining of the nasal mucus or scrapings from ulcerations on nasal septum for leprosy bacilli. These are often found in the characteristic cigar package bundles or engulfed in lepra cells. A standard procedure is to give 60 grains of iodide of potash to cause a drug coryza, in the secretions of which leprosy bacilli may be found. However, one will have better success if the nasal secretion be obtained at a time when a natural coryza exists.
Thibault examined the nasal mucus, gland juice and blood of 30 lepers. He obtained leprosy bacilli in the nasal mucus of 20, in the gland puncture juice of 18, and in the blood of 7.
Hollman detected leprosy bacilli in the nasal mucus of 90% of 58 nodular cases, of 67% of 6 mixed leprosy and of 45% of anaesthetic cases, after making 329 examinations.
Leprosy bacilli are apt to be found in the blood of nodular cases, especially at the time of the febrile accessions. The blood is best taken in 5 or 10 cc. quantities into[264] 1% sodium citrate in distilled water. After centrifuging, the sediment is treated with 10% antiformin, at 37°C. for one hour. Again centrifuging, and washing, the sediment is smeared out on a slide and stained. The bacilli are not apt to be found in the blood of cases of nerve leprosy.
Smith and Rivas add 10 vols. of 2% acetic acid to 1 vol. blood, centrifuge and make smears.
Gland puncture has recently been considered as an important diagnostic procedure in leprosy.
It must not be forgotten that while the finding of leprosy bacilli is usually very easy in the nodules of nodular leprosy it is a painstaking and discouraging procedure with the spots of nerve leprosy. Even the affected nerves, at autopsy, often fail to show bacilli. For nerve leprosy the examination of nasal mucus is of prime importance.
The Roentgen ray has been utilized in the recognition of the very early, trophic changes in bone, showing the commencing absorption of phalanges. Neve has reported a case in which there were no satisfactory indications of leprosy other than slight deformity of toes and fingers but showing marked changes in the phalanges, even to disappearance of terminal phalanx of some toes when examined with X-ray.
Prognosis
The progress of the disease is so slow that it is difficult to estimate improvement or cure. At present the possibility of a cure, with the new methods of treatment, is encouraging. There is no doubt but that many of the reported cures have simply been instances of remissions in the course of the disease for periods covering months or even three or four years. It would seem that the earlier treatment is instituted the greater the possibility of cure. There were 38 cases officially reported as cured, in Norway, from 1881 to 1885.
Nodular leprosy runs its course much more quickly than does nerve leprosy. It is in nodular leprosy particularly that intercurrent affections carry off the patients. Tuberculosis carries off about 23% of cases and nephritis almost 30%, while a combination of tuberculosis and renal disease about 10%. In the remainder, the cachexia or accidents of leprosy itself are responsible for a large portion of the deaths. Cases of nodular leprosy are more often carried off by kidney disease than those with nerve or mixed leprosy.
It must not be forgotten that lepers, especially those with the nerve form, may live for twenty to forty years.
Prophylaxis and Treatment
Prophylaxis.—As was noted under epidemiology there seems to be little evidence to show that insects play any part in the transmission of[265] leprosy. Nevertheless it would seem advisable to prevent flies from becoming contaminated with the discharges from leprous ulcerations which so often teem with leprosy bacilli. This possible method of transmission would seem more deserving of attention than the question of the taking up of bacilli from the blood by mosquitoes, bedbugs or biting flies, as the leprosy bacilli are found in the blood of nodular leprosy chiefly during the febrile accessions and very rarely in the blood of cases of nerve leprosy. In all of the ordinary insects the bacilli seem to disappear in a very short time, with the exception of the cockroach, for which reason it would seem advisable to destroy these pests, which can be easily done by sprinkling around a little sodium fluoride.
There is some evidence that scabies favours infection so that this disease should be looked for and actively treated in endemic areas.
Leprosy tends to spread where there is marked personal uncleanliness and close contact with lepers in overcrowded quarters. Many authorities consider the free use of soap and water the most important means of avoiding infection. While segregation is generally considered the one proven prophylactic measure there are those who question its value. There does not seem to have been any very marked influence on the spread of leprosy among the native Hawaiians through the enforcement of isolation of such cases. Partial segregation at their homes has given very satisfactory results. Where a leper is not excreting bacilli, or where acid-fast organisms cannot be found after careful search there is no danger. Such patients, however, should report for examination every few months. Evidence as to contact indicates that all young children are particularly liable to the infection, as has been noted for children of lepers and brothers and sisters. Even if segregation of lepers is not carried out as regards adults, it should be the rule for children, so that infants and young children should be separated from their leper parents or parent. A very remarkable feature in connection with leprosy is the hysterical dread that many communities have of a leper, when they must know or could easily learn, that the contagiousness of the affection is so slight, that notwithstanding our efforts, we can scarcely point to a single instance to prove undoubted transmission of the disease from one person to another. At any rate knowing that immense numbers of the bacilli are given off from ulcerations and the nose, we should guard against the dissemination of leprosy bacilli from such sources.
Treatment.—Many so-called specific products, whether of the nature of extractives, as leprolin or nastin, or of bacterial vaccines, have been tried with results which have not tended to gain the confidence of conservative men. The product which has been given most general trial is nastin. This is a neutral fat, extracted from a streptothrix growth, obtained by Deycke from leprous nodules. It is combined with benzoyl chloride and is contained in ampoules containing from one-half to one-fifth of a milligram.
Wise and Minett treated 244 cases with nastin for periods of from one to two years, the treatment having been at first supervised by Deycke himself. It was stated that nodular cases did not seem to be improved and that anaesthetic leprosy was not apparently influenced.
Minett mentions the efficiency of a 2½% solution of benzoyl chloride as a nasal spray and as an application to leprous ulcers, this treatment causing the bacilli rapidly to disappear from the discharges of nose or ulcers. On the other hand Scott, in Assam, reports practically 50% of cures, or cases greatly improved, in patients treated with nastin for a year or more. He gave nastin B1 injected intramuscularly at two weeks intervals.
Salvarsan does not seem to have been of any value in leprosy.
The standard treatment for leprosy is chaulmoogra oil given internally, in capsules, in doses of 5 to 10 minims increased gradually, according to stomach tolerance, to 40 to 60 minims.
For hypodermic use Heiser makes a mixture of 60 cc. each of chaulmoogra oil and camphorated oil with 4 grams resorcin. Injections are made weekly, commencing with 1 cc. This dose is increased steadily according to tolerance, but in some patients marked reaction in the lesions, with fever, occurs after a dose of only a few cubic centimeters has been reached.
Rogers has for some time been giving subcutaneous injections of sodium gynocardate, the sodium salt of the lower melting-point fatty acids of chaulmoogra oil. Finding that large doses of sodium gynocardate could be administered to animals with safety he has recently given intravenous injections and has substituted this method for the subcutaneous one. For use in the treatment of leprosy he prepares a 2 or 3% solution in distilled water and, after sterilization in an autoclave, adds ½ per cent. carbolic acid. The solution should be quite clear. He starts with one-tenth of a grain and increases the dosage by one-tenth with each successive injection up to four-fifths of a grain. He states that this method has as great superiority over the subcutaneous one as that has over the administration of chaulmoogra oil by mouth. Rogers now uses a solution of 3% sod. gynocardate with 1% phenol and 1% sod. citrate. At first the intravenous injection is with 0.5 cc. thrice weekly, which dose is gradually increased up to as much as 5 cc.
It is possible that sodium morrhuate (cod-liver oil) may be as efficacious as the gynocardate salt. Rogers has used Hydnocarpus instead of the true chaulmoogra oil and thought he obtained better results. One explanation of the uncertainty of success with chaulmoogra oil is the difficulty of securing oil obtained from proper sources. The standard treatment of leprosy in Honolulu, as reported by McDonald, is the weekly injection of the ethyl esters of the entire fatty acids of the whole chaulmoogra oil, with 2% by weight of iodine, chemically combined. The treatment begins with 1 cc. injected intramuscularly, increased by 1 cc. at every second or third injection, until a dose of from 2 to 6 cc. is reached, according to age and weight of patient.
For internal use the mixed fatty acids, carrying 2½% iodine, chemically combined, are given in capsule. The dose by mouth is 0.25 grams per 100 lbs. weight, three times daily, an hour or two after meals. This is gradually increased every two weeks until a maximum dose of 1 gm. per 100 lbs. weight is reached.
Dyer combines hydrotherapy with the administration of chaulmoogra oil. He gives a daily bath as hot as can be borne, and, in addition to the specific treatment, gives 1/60th grain of strychnine three times daily.
Antileprol, a preparation of chaulmoogra oil, which is more satisfactory than oil, may be given in doses approximating 120 grains by mouth daily or 60 grains subcutaneously. Such drugs as arsenic salicylate of soda and bichloride of mercury have been used.
Thyroid extract has seemed to benefit cases of anaesthetic leprosy in rare instances. The high frequency current with the needle applied to the nodular lesions has been recommended by Unna. Radium and X-rays have also been employed. There have been reports as to the value of the antimony treatment in leprosy.
Leprosy is a disease in which improvement often occurs when the patient is placed under more favorable conditions as to food, climate, etc. Again, there is at times a tendency for the disease to abort or ameliorate without relation to treatment or environment.
Surgical treatment is frequently of use, as nerve stretching for the leprous neuralgias. Various eye operations are necessitated by the ectropion or leprotic iritis. The amputations of the area involved in perforating ulcer is recommended. Tracheotomy is often demanded for the laryngeal stenosis.
McCoy has combined carbon dioxide snow local treatment with chaulmoogra oil. The lesions showed decrease in size but remained bacteriologically positive.
SECTION III
FOOD DEFICIENCY DISEASES
CHAPTER XVIII
BERIBERI
Definition and Synonyms
Definition.—Beriberi is a food deficiency disease due to the absence from the dietary of a neuritis-preventing vitamine. It is particularly important among the people of the Orient whose diet is preponderatingly one of rice. In milling the grain the outer vitamine-containing layers are rubbed off and this polished rice, when the chief constituent of a dietary, is capable of causing, after a period of two or three months, a peripheral neuritis.
This neuritis not only involves the nerves of the extremities but, as well, the pneumogastric, and it is the manifestation of cardiac disturbances which best differentiate this form of neuritis from those due to alcohol or arsenic.
The disease is usually described under two types: (1) a wet or dropsical beriberi, in which the vasomotor nerves are affected with resultant general oedema and (2) a dry atrophic or paraplegic type, in which muscular palsies and atrophies are the leading features. Pathologically, we have a Wallerian degeneration of the peripheral nerves with possibly axonal degeneration of the cells of the neuron involved.
Synonyms.—Neuritis Multiplex Endemica, Polyneuritis Endemica, Hydrops Asthmaticus. Japanese: Kakke.
History and Geographical Distribution
History.—While modern knowledge of beriberi may be said to date from the writings of Bontius, in 1642, yet the disease is distinctly described by Chinese writers of the seventh century and treated in writings of the second century and possibly referred to in writings as ancient as B. C. 2697. It is probable that the disease described by Strabo as occurring in a Roman army while invading Arabia, in[269] 24 B. C., was beriberi. While mention of the disease may be found in Japanese writings of the ninth century it is thought by Scheube that this relates to the disease in China and that beriberi first appeared in Japan about the eighteenth century. Bontius described the atrophic form of the disease, Rogers, in 1808, the serous effusions, and Marshall, in 1812, noted two types, barbiers, when the paralysis predominated, and beriberi, when the dyspnoea and oedema were leading features.
In 1835 Malcolmson noted that cases of beriberi assumed the type of barbiers and vice versa, from this time the view has obtained that the two affections belong to one disease.
The disease seems to have first made its appearance in Brazil in 1866.

Geographical Distribution.—Reference to the chart will show 3 markedly endemic centers for beriberi, one embracing Japan, a second the Dutch East Indies (Java, Borneo, Sumatra), and a third, involving the Eastern coast of Brazil. In somewhat less degree the disease prevails in India, Indo-China, Malay Peninsula, Eastern China, and the Philippine Islands. It is also found in the regions of the East and West Coasts of Africa, and was devastating to the laborers on the Congo railway. It has been reported from many parts of the world among coolies from Asiatic countries. A disease of similar nature has been noted in asylums in England and America. Beriberi occurred among the British soldiers in Mesopotamia during the recent war—more than 300 cases in 1915. It is interesting to note that scurvy, and not beriberi, occurred among the Indian troops in Mesopotamia at this time. There was no scurvy in the British troops.
Etiology and Epidemiology
Etiology.—There is probably no disease about which there exist so many views as to etiology as with beriberi. Many of those formerly[270] advanced are so negatived by recent investigations that it would seem hardly worth while to mention them. While the cause is still unsolved attention is at present almost exclusively directed to some deficiency of a neuritis-preventing substance in the dietary and such studies have in large part centered about the question of such deficiencies in certain kinds of rice.
Reserving until the last the discussion of the rice theories we may briefly dismiss such views as those assigning bacterial or protozoal causes with the exception of those of Manson and Hamilton Wright.
Manson’s Theory.—Under conditions of overcrowding, filth, warmth, moisture and lack of ventilation, as would obtain in the forecastle of a ship carrying a native crew, the development of a hypothetical germ is favored. This germ in its growth gives off emanations which like alcohol act as toxins upon the peripheral nerves. The germ itself does not infect the patient.
Wright’s Theory.—According to this view a bacillus which was given off in the faeces was ingested and locating in the duodenal mucosa gave off a toxin similar to that of the diphtheria bacillus. Instead of developing its soluble toxin in the membrane of the region of the throat this action took place in the upper part of the small intestines.
Of the bacterial causes may be mentioned: (1) The coccus of Pekelharing and Winckler. This organism was supposed to be short lived in the body and repeated infections were necessary to produce the disease.
(2) Dangerfield held views somewhat similar to those of Pekelharing and thought a coccus in the alimentary canal the cause.
(3) Isuzuki regarded a coccus isolated from the urine as the cause.
(4) Okata and Kokubo thought a coccus obtained from the blood to be the infecting agent.
Various bacilli, other than that incriminated by Wright, have been brought forward as pathogenic agents but it may be stated without further discussion that the claims of the advocates of bacterial causes have not been verified and are solely of historical interest. The same statement will hold for the plasmodium-like protozoon of Glogner which was found in the splenic blood.
Of the chemical theories may be mentioned; (1) Arsenic poisoning. In an outbreak of arsenical neuritis in England, from arsenic contained in the glucose used in making beer, Ross diagnosed the illness as beriberi. Subsequently, arsenic was found in the hair of certain patients with beriberi, hence the theory which has never been substantiated. It may be stated that a careful study of this epidemic by Reynolds and Bury indicated that the alcoholic factor was also operative as persons taking an equal amount of arsenic but without alcohol, did not develop neuritis.
(2) Treutlein’s oxalate theory.—This was based on the fact that polyneuritis gallinarum could be produced in fowls by feeding them oxalic acid.
Of the food deficiency theories, the most prominent is (1) that of Takaki, generally designated the nitrogen deficiency theory. As the[271] result of increasing the proteid constituents of the ration of the Japanese Navy from 109 to 196 grams, the disease was largely eliminated (from about 32% incidence to less than 0.5%).
In the old ration the ratio of N to C was as 1 to 17—32, in the new ration, 1—16. In looking over the constituents of the new ration the addition of about 100 grams of beans is noted. These are rich in vitamines.
(2) According to Fales the hypothetical germ of beriberi can only live in body fluids deficient in potassium carbonate. The high content of potash in potatoes made him greatly increase the amount of this vegetable in the dietary he recommended. Fales noted scurvy as well as beriberi in the Bilibid prisoners on a diet deficient in potash.
(3) Deficient fat. (4) Deficient phosphorus.—It was Schaumann’s idea that the phosphorus contained in the outer layers of the rice grain was essential in the prevention of beriberi. While it is now known that the beriberi-preventing substance does not contain phosphorus, yet the idea has proven of practical value as giving an index of beriberi-producing power of rice.
P2O5 Index of Beriberi-producing Rice.—If a rice contain under 0.4% of phosphorus pentoxide it is liable to produce beriberi.
Schaumann now considers that the antineuritic substance in rice polishings acts as an activator in the metabolism of phosphorus.
Vitamine Deficiency.—Grijns was the first to insist that beriberi was due to the absence in the diet of some substance essential to proper metabolism of the peripheral nerves. His views were along the line of our present vitamine deficiency ones. There are undoubtedly many different vitamines, varying as to nature of protective power, temperature at which destroyed, solubility, etc. McCollum emphasizes the importance of a fat soluble A and a water and alcohol soluble substance B for proper metabolism. This latter, usually designated “Water soluble B,” is generally considered the same as the anti-neuritis vitamine but there is recent evidence that this may not be the case. The antiscorbutic vitamine is water soluble C.
Food Poisoning as Cause.—There are other theories as to intestinal parasites causing the disease and in particular views as to relation of fish eating to the disease, which are (1) that it is caused by the ingestion of raw fish, or again (2) from the eating of certain poisonous fish.
Miura, who is the great advocate of a fish intoxication, believes that this comes about from eating fish belonging to the Scomberidae family. As proving this, he cites the absence of beriberi in prisons in Japan, where no fish is allowed. He does not recognize that it is the diet of barley 6 to rice 4 parts which is the prophylactic factor. Barley is rich in vitamines.
Rice and Beriberi
There are a few points in connection with rice which should be understood. The larger part of the rice grain is starch and covering this central starch core we have the rather thin aleurone layer containing the proteid and fat constituents of the grain. Externally there is an adherent layer, the pericarp, which varies in color from red to white according to the kind of rice. The pericarp contains the salts. The grain is covered by the husk which is always removed to render the rice suitable for food. Unhusked rice is called padi in India and palay in the Philippines. In the process of removing the husk (milling) the pericarp and more or less of the aleurone layer may be rubbed off the grain. When the milling process is carried to the extent that but little remains except the starch the rice is termed polished, highly milled, or white rice. A process of parboiling causes the husk to be more easily detached and the pericarp to adhere more firmly to the grain and when milled there is less loss of the anti-neuritis principle, which is contained in the outer layers. Such rice is called cured rice. The embryo also contains the anti-neuritis vitamine as well as the fat soluble A one. It is also lost in milling. The scale-like dust is termed rice polishings and has curative value for those who have developed beriberi under a diet of polished rice. When the milling process is less complete the rice so treated is called undermilled rice or red rice. Polished, highly milled or white rice contains as a rule less than 0.4% of phosphorus pentoxide while the beriberi-preventing rices contain more than 0.4% of this compound for which reason legislation has required rice to have more than 0.4% phosphorus pentoxide.
Siam rice is a polished white rice which contains about 0.25% phosphorus pentoxide and has more often been associated with severe outbreaks of beriberi than Rangoon rice, which has about 0.32%, this latter, however, being a well-recognized beriberi-producing rice. Unpolished rice contains about 0.55% of phosphorus pentoxide. Natives generally prefer the polished rice because it is clean and free from weevils, while the undermilled kind is dirty. Parboiled rice has a disagreeable odor.
Voegtlin has recommended a P2O5 requirement of 0.5% for corn products and 1% for wheat ones. Thus whole wheat contained 1.12% while highly milled flour had only 0.114%. Fowls fed on this flour developed polyneuritis in twenty to thirty-two days.
Whole corn contains 0.76% P2O5, while highly milled corn grits has approximately 0.2%, and highly milled corn meal about 0.3%. These highly milled corn products produced polyneuritis within from thirty to thirty-five days.
With rock ground corn meal, containing 0.7% P2O5 the fowls remained well.
Experiment of Fraser and Stanton.—While there have been numerous instances reported to show the connection between polished rice and beriberi, when such rice was the predominating article of diet, it will suffice to refer to the experiments of Fraser and Stanton and of Strong.
In 1909, Fraser and Stanton experimented with 493 Javanese coolies who were employed in building a road far removed from any village which might introduce the factor of bacterial etiology into the problem. They noted that the Javanese prefer white rice, and reference is made to the fact that many cases of beriberi[273] occurred among these laborers in 1906, which outbreak ceased upon requiring them to eat parboiled rice at the suggestion of Doctor Braddon. They state that they informed the coolies of the danger of white rice but, notwithstanding, they all expressed a preference for the white rice over parboiled rice. For the purpose of comparison, only one-half were allowed the white rice diet. The two parties were quartered in virgin jungle and were isolated from each other by an interval of 7 miles. Of 220 individuals on white rice there were 20 cases of beriberi recorded while among 273, who lived on parboiled rice, no cases occurred.
Prolonged Continuation of Faulty Diet Necessary.—It appeared that a considerable period of continuance of white rice diet was necessary before the appearance of the disease (eighty-seven days). As against the infectious nature of the disease they note that contact of persons on a parboiled rice diet with the beriberi cases was without result. Substitution of parboiled rice for white rice brought about a cessation of the outbreak.
The Philippine scouts, numbering about 5000 natives, gave 618 cases of beriberi in 1908 and 550 cases in 1909. In 1910 undermilled rice was substituted for polished rice and they were required to eat 1-6 oz. beans daily. No other change in their mode of living was made. By 1913 beriberi had disappeared among them, although the disease still prevailed among the native population in contact with them.
Experiment of Strong and Crowell.—Strong and Crowell stated that the object of their study was to determine whether beriberi, as it occurs in the Philippines, is an infectious disease or whether it is one which has its origin in disturbances of metabolism, due chiefly to the prolonged use of polished rice as a staple article of diet.
The experiments were carried out in Bilibid prison. Prisoners, who had been condemned to death, were informed of the nature of the experiment and were told of the diet on which it was proposed to place them. They were also told that they might contract beriberi. Twenty-nine volunteered and each signed a statement in his own dialect that he undertook the experiment voluntarily.
In general, the groups were fed for the greater part of the time occupied by the experiments as follows: Group (1) “White rice and extract of rice polishings and special diet.” Group (2) “White rice and special diet.” Group (3) “Red rice and special diet.” Group (4) “White rice and special diet.”
Of 6 men on the Group 1 diet, 2 developed beriberi. The symptoms however, were not marked, being chiefly loss of weight, tachycardia, slight oedema of legs and tenderness of muscles of calves. Four of the 6 men of Group 2 developed beriberi and 6 out of 11, in Group 4, showed symptoms of beriberi. In Group 3, only 2 in 6 developed symptoms and these consisted in case No. 13 only in tenderness of epigastrium, paraesthesia, cardiac disturbance and marked diminution of knee jerk. In case No. 18 there was noted only slight cardiac disturbance and epigastric pulsation.[274] In none of the cases was the complete picture of beriberi obtained except in those in which the white polished rice formed the staple article of diet, but in one case, fed on red rice, the diagnosis of beriberi was almost definite.
The results of their experiments with the addition of rice polishings to the diet would indicate that whatever may be the results obtained with extracts from this material in preventing polyneuritis of fowls or in curing it after it has developed it is not as efficient in man as the cheaper and more readily obtainable mongo or katjangidjo bean or yeast.
Evidently symptoms of beriberi may also sometimes occur in individuals fed on red rice as a staple article of diet when the diet is very monotonous, comprising few articles and continued for long periods of time. From the experiments it is evident that beriberi may be produced by the prolonged consumption of white rice as a staple diet. Of 17 individuals fed on such diet 8 developed beriberi, all with distinct loss of knee jerk, as well as with other marked symptoms of the disease. Symptoms appeared within 61 to 75 days after the commencement of the diet.
Vedder thinks that the red rice used in these experiments may not have been sufficiently undermilled, as it was found most difficult to obtain such a beriberi-preventing rice for the Philippine scouts. As regards the lack of success with extract of rice polishings the same author considers that a sufficient amount of alcohol for the extraction of the vitamines was not used in the above experiments, as he found it necessary to use 30 litres of alcohol to 5 kilos of rice polishings. Strong and Crowell used only 14 litres of 95% alcohol to 5 kilos of polishings.
Braddon’s views.—Prior to the investigations of Fraser and Stanton the importance of the rice factor in the etiology of beriberi was insisted upon by Braddon who thought that a poison was elaborated by some organism which poison was contained in the beriberi-producing rice. This development was thought to occur in rice stored in damp places, but Vedder has shown that storing undermilled rice in a damp place for a year does not cause it to lose its anti-beriberi-producing properties.
Endocrine Gland Disturbances and Beriberi.—We owe in particular to the researches of McCarrison our appreciation of the important rôle of the endocrine glands in deficiency diseases. With dietaries deficient in vitamines he noted in birds and other animals hypertrophy of the adrenals, atrophy of the thyroid, thymus, testicles and ovary. The pituitary was unaffected. Vitamine deficiency seems to impair the activity of the thyroid and to thus favor the action of products of intestinal bacteria. It is now accepted as important this secondary factor of bacterial infection in all types of food deficiency pathology. Dietaries rich in fats and proteins with sufficiency of vitamines bring about thyroid hyperplasia. In a diet too rich in carbohydrates and deficient in vitamines marked endocrine disturbances are noted.
The adrenals show hypertrophy on a vitamine-deficient diet and this hypertrophy is associated with increase of the adrenalin content of the glands. Oedema seems to be associated with adrenal hypertrophy. McCarrison believes the oedema to be associated with increased intracapillary pressure from the effect of adrenalin but others dispute the explanation. The adrenalin content of the enlarged adrenals varies; it is in excess with a diet rich in carbohydrates and deficient in proteins and vitamines, but is below normal when the diet is scurvy-producing. Butter, probably from its fat soluble A content, seems to protect against oedema.
Polyneuritis gallinarum.—The work of Eijkman in showing that polyneuritis could be produced in fowls by feeding them on polished rice and prevented when a diet of rice polishings was added to the neuritis-producing rice opened the way for a vast amount of experimental work. As regards the nature of the neuritis-preventing substance in the rice polishings it was soon found that it had no relation to the phosphorus content. Funk has isolated a substance he calls vitamine, a pyramidine base precipitated by phosphotungstic acid, which is present in rice polishings and seems to possess extraordinary curative properties in polyneuritis gallinarum. Heart muscle, egg yolk and yeast are rich in this anti-neuritis substance, which is also present in lentils and barley.
Various Vitamines.—The anti-neuritis vitamine is soluble in water and alcohol and is comparatively thermostable (destroyed by a temperature of 120°C. in two hours). It is affected by alkaline reaction but is stable in acid solution. The water soluble B vitamine does not seem to be destroyed by a temperature of 120°C. for two hours, hence it may be different from the anti-neuritis one. The antiscorbutic vitamines differ in being thermolabile, these factors in certain foods being destroyed by a temperature of 60°C. Another vitamine, fat soluble A, found particularly in butter, seed embryos and leaves of plants, is a food essential. Its absence from a diet causes xerophthalmia. Cod-liver oil and glandular organs of animals contain it.
Schaumann considers malt as richer in the anti-neuritis vitamine than any other article of diet, rice bran coming next. Many think that vitamines have not as yet been separated but that they are intimately combined with some mother substance in the food.
There is, in all probability, a large number of vitamines present in various animal and vegetable foods, the deficiency of which in a diet[276] may lead to vague disorders or to well-recognized diseases, such as scurvy, ship beriberi, beriberi or pellagra.
Schaumann considers the curative principle to be of the nature of an activator. An increase in the ingestion of carbohydrates and necessarily in the vitamine as well seems to produce neuritis more rapidly than where a smaller amount is given, this indicating the importance of these vitamines in carbohydrate metabolism.
There are those who deny this carbohydrate metabolism function of vitamines and it is a fact that polyneuritis of fowls will develop on a diet from which carbohydrates are excluded.
In epidemics of beriberi it has been observed that those who eat most rice are more often attacked, thus men more frequently than women. A temperature of 120°C. destroys the vitamine. Owing to the absence of rice as a constituent of other than slightest importance in the dietary of Brazilian cases of beriberi, as well as from numerous reports of the occurrence of the disease in nonrice-eating persons, the view that is now entertained is that not only polished rice, but any predominating carbohydrate article of diet, which is deficient in the neuritis-preventing substance, can produce beriberi. Wellman and Bass have shown that such articles of diet as sago, boiled white potatoes, corn grits and macaroni practically parallel polished rice in the production of polyneuritis in fowls.
Predisposing Causes.—There does not seem to be any racial predisposition other than that associated with the more varied and the more neuritis-preventing diet of the white race. For the same reason beriberi is more prevalent among the poor than among the prosperous classes of countries where the disease exists extensively.
It is customary to consider as predisposing causes bad hygienic surroundings, such as occur in jails, camps, etc., as well as the influence of warmth and dampness of the atmosphere. Beriberi is more common among men than women and affects most commonly individuals between 15 and 30 years of age. Physical exhaustion, excessive grief, digestive derangements, abuse of alcohol and tobacco are considered to have a bearing in the production of the beriberi symptoms. Surgical operations may be followed by manifestations of the disease.
Epidemiology.—Inasmuch as the experiments of Strong force us to the conclusion that the disease is not infectious, the study of the prevention of the disease would appear to rest almost exclusively in the question of a neuritis-preventing dietary.
In this connection Heiser, in the Philippines, has reported that with a diet in which polished rice was contained the monthly death rate at the leper colony at Culion was approximately 100, the majority of these deaths being from beriberi. As a result of the substitution of unpolished rice, about 1909, the monthly death rate fell to less than 20 and of these none were from beriberi.
Toward the close of 1911 there was a great shortage of the rice crop and the Philippine government bought quantities of rice in order to protect the people from extortionate dealers. Much of this rice was polished rice. The use of this polished[277] rice was commenced at Culion in November, 1911. In January, 1912, there were 35 deaths, of which 2 were from beriberi. In February 86 deaths with 36 from beriberi and in March 82 deaths with 60 from beriberi. In February the use of polished rice was discontinued and unpolished rice substituted. In April the deaths had fallen to 25 with 3 from beriberi and, subsequent to that month, deaths from beriberi cases developing at Culion ceased to be reported.
As regards the length of time necessary for the production of the symptom-complex, Strong’s experiments show that beriberi was produced in from sixty-one to seventy-five days. In Fraser and Stanton’s work no case developed under eighty-seven days and many of the cases did not develop for 120 to 160 days. Hamilton Wright considered that the incubation period for his toxin-producing bacillus was ten to thirty days.
Pathology and Morbid Anatomy
In polyneuritis gallinarum, Vedder and Clark are of the opinion that there may be two vitamines involved, the absence of one from the dietary causing the neuritis, while that of the other leads to general prostration and cardiac degeneration, so that there may be other factors in the production of beriberi than the degeneration of the peripheral nerves and involvement of the vasomotors.
Furthermore, extract of rice polishings rapidly cures the cardiac condition as well as the dropsy, but not the paresis; while Funk’s vitamine base, which will cure the paralysis, will not affect the cardiac disorder.
The blood of beriberics in the acute stage, has been shown to contain a substance capable of profoundly influencing the vasomotor functions, causing venous engorgement and a fall of blood pressure.
In deaths from wet beriberi the tissues are very moist so that incisions tend to fill with fluid. There are generally present pleural and in particular pericardial effusions. Serous fluid in the abdominal cavity may also be present. The lower end of the stomach and the upper portion of the small intestines, in particular the duodenum, show marked congestion with more or less abundant haemorrhagic extravasations. Some authorities do not admit the existence of this duodenal congestion so insisted upon by Wright.
The oesophagus is usually congested as may be also the pharynx and the larynx.
Next to the peripheral nerve degenerations, to be later considered, the most important lesions are found in connection with the heart. All chambers of the heart show a dilatation with hypertrophy as well as dilatation of the right ventricle in cases that have lasted for some time. The heart muscle has the faded-leaf appearance indicative of fatty degeneration. Microscopically there are segmentation and vacuolation of the fibres. The lungs show congestion and at times present the characteristics of pulmonary oedema. The kidneys are congested but show only exceptionally parenchymatous or interstitial changes. As would be expected, the back pressure in the right heart gives a dilatation of the central vein of the liver lobules which at times is productive of atrophy of the adjacent liver cells. The[278] muscles supplied by the affected peripheral nerves show more or less atrophy according to the duration of the disease.
Microscopically, the affected fibres show a loss of striation with a colloid degeneration. These changes are more marked in beriberic residual paralysis. The key to the disease is in the changes present in the peripheral nerves. While these may appear normal yet histological examination shows varying nerve degenerations from slight medullary degeneration in a few fibres to complete destruction of the nerve, giving a Wallerian degeneration (vacuolation and formation of myelin droplets in the medullary sheath with fragmentation of the axis-cylinder).
While it is usually stated that the central nervous system (brain and cord), remains uninvolved yet we note axonal degeneration in the cells of the nuclear centres of the affected peripheral nerves as shown by convexity of the cell sides, dislocation of the nucleus and disappearance of the tigroid substance. The striking feature of the pathology of beriberi is the involvement of the vagus nerve and there is evidence of degenerative changes in the cells of the vagal origin in the floor of the fourth ventricle.
Various investigators have shown that in fowls marked peripheral neuritis can exist long before clinical manifestations appear and that typical cases of beriberi may show striking improvement following vitamine administration, notwithstanding the continued existence of peripheral nerve degeneration. For such reasons Vedder thinks the more important changes to probably belong to cells of cord and brain.
McCarrison has noted striking changes in the endocrine glands in avian polyneuritis, particularly hypertrophy of the adrenals and atrophy of the other glands of internal secretion. He attributes the oedema to increase in adrenalin content. Shimbo has reported adrenal hypertrophy in 14 human cases of beriberi.
Symptomatology
It is well to remember that beriberi is but a form of multiple neuritis which in many cases shows only motor and sensory disturbances of the lower portions of the upper and lower extremities.
In fact an extensive epidemic of arsenical neuritis, or, to be more exact, a neuritis in which both alcoholic and arsenical factors were operative, was regarded by eminent authorities as beriberi.
The key to beriberi, however, is the peculiar and striking selection of the vagus nerve in the degenerative processes as well as those of the peripheral nerves of the extremities. It is vagal involvement, giving disturbances of heart particularly and lungs in less degree, which chiefly differentiates beriberi from other forms of multiple neuritis.
Another peculiarity of beriberi is the tendency to vasomotor involvement as shown in the patchy areas of oedema.
Epidemic Dropsy.—Beriberi is typically a nonfebrile disease. There is, however, a disease with fever, called epidemic dropsy, which[279] seems to have a similar etiology to beriberi. It also shows the symptoms of a peripheral neuritis plus cardiac disturbances. In fact Pearse has maintained the identity of the two diseases. Greig considers epidemic dropsy as resembling ship beriberi.
The first record of epidemic dropsy was during a famine in Southern India in 1877. Outbreaks again occurred in 1902 and 1907. The fact that it is a disease which often shows a house infection has caused the advancing of a theory that the bedbug transmits the disease.
While greatly resembling beriberi clinically the following points of difference are usually noted by those who hold that it is a distinct disease entity.
1. The presence of fever, which rarely exceeds 102°F. and is usually only about 99° to 100°F.
2. An erythematous rash upon the oedematous portions of the extremities.
3. The frequent generalized oedema, which suggested the designation dropsy for the disease, cannot be differentiated from wet beriberi.
4. The neuritis manifestations are slight or absent. There may be formication of the feet but anaesthesia is wanting. The vagal involvement gives cardiac disturbances. There is anaemia.
Infantile Beriberi.—There is also a condition in nursing infants which would be difficult to recognize if unaware of the existence of this type of beriberi. It is called infantile beriberi.
In 1898 Hirota first noted the existence of a condition in infants nourished by beriberi mothers which has more recently been carefully studied by McLaughlin and Andrews and to which the name infantile beriberi is now generally given. In the Philippines it is called “taon.” Clinically there is restlessness, vomiting, altered voice, increased heart action, oedema and cyanosis. After death there is found a marked hypertrophy and dilatation of the right side of the heart with no change of the left side. The peripheral nerves also show the lesions of beriberi of adults but of less intensity.
The disease most often shows itself in an acute form, the child rather suddenly being seized with great pain, crying constantly and soon becoming cyanosed. Death, which may occur in a few minutes or hours, is often thought to be due to meningitis, although there is no fever or true convulsions. There is only rigidity of the body. Less frequently the disease appears in a chronic form in which vomiting and constipation are most marked. There is often a history of the loss by the mother, who herself may have only a rudimentary beriberi, of several children from this disease.
The infants improve rapidly when other infant feeding is substituted for the mother’s milk. An extract of rice polishings gives striking results in these cases.
Asylum Beriberi.—The beriberi outbreaks which have frequently been reported from European and American camps, prisons and asylums do not differ from the cases one may see in the classical distribution of the disease among the rice-eating populations of the Orient. The cause is the same, a deficiency in beriberi-preventing vitamines, and the symptoms are similar. These vitamines may be deficient in the[280] rice or other cereal or proteid food supplied. Again they may have originally been present in sufficient quantity but later destroyed by too great heat or otherwise.
Types of Beriberi.—The ordinary clinical division of beriberi is into (1) wet or dropsical beriberi and (2) dry or atrophic beriberi. At the same time, in a typical case, we find such a combination of the vasomotor disturbances which lead to the oedematous or dropsical manifestations of wet beriberi, and likewise of those of peripheral nerve involvement causing more or less development of muscular palsies or atrophies, as seen more strikingly in dry or atrophic beriberi, that it does not seem advisable to employ such a division.
In fact typical cases of wet or dropsical beriberi after a profuse diuresis may change in a short time, as Manson has so aptly stated, from a bloated carcass to little more than skin and bones and assume all the appearance of a case of dry or atrophic beriberi.
Even Vedder, who states that from a theoretical standpoint wet and dry beriberi may be considered separate pathological processes (deficiency in the anti-cardiac degeneration vitamine rather than the anti-neuritis one), is inclined to believe it inadvisable, from a clinical standpoint, to consider the one type apart from the other.
One sees cases which combine the features of dry and wet beriberi which can best be designated typical beriberi. Again we see cases where the vagal and vasomotor involvement is so marked that the patient resembles a man with acute nephritis plus all the evidence of extreme cardiac decompensation. Such cases may be designated fulminating, pernicious or better cardiac.
Again we observe cases which from the start show little if any oedema and very slight cardiac involvement, but with marked motor disturbances as shown by muscular atrophies and palsies. The sensory changes are not so marked as the motor ones. Complete anaesthesia is rarely present, it is rather paraesthesia and blunting of sensation which characterize the sensory phenomena. This is usually designated the atrophic or paraplegic type.
Rudimentary or Larval Beriberi.—Scheube recognizes a rudimentary type and it must have been the experience of every one in the tropics that these indefinite types of beriberi are quite common.
In such cases there may be nothing more than some weakness of the legs with vague manifestations of blunting of the sensation or variation of the reflexes. At times there may be marked anaesthesia in the region over the shin bones.
Many of these cases show cardiac palpitation on exertion and at times we may note slight evidences of oedema about the lower part of shin bone or dorsum of the foot. It is the frequency of such cases that causes physicians in the tropics to consider almost any affection showing neurological manifestations as of beriberi nature. A[281] careful study of the neurological features of cases in the tropics will show that many of these cases are not beriberi but rather the common cosmopolitan diseases of the nervous system.
A Typical Case of Beriberi.—The patient first complains of weakness and heaviness of the legs, particularly after fatiguing work. There is also noted a sense of fullness and tenderness in the epigastric region. The slightest exercise brings about cardiac palpitation and more or less dyspnoea.
As the symptoms of peripheral neuritis become more prominent we have hyperaesthesia of the calf muscles so that squeezing these muscles gives rise to rather marked pain. The thenar muscles or those of the forearm may also be more or less hyperaesthetic. Attention has been called to a circumoral anaesthesia.
An examination at this time will probably show an active patellar reflex, some oedema over the shin and malleoli, possibly extending to the dorsum of the foot, with partial anaesthesia in the oedematous areas. It is a blunting of sensation as though a layer of cotton were interposed between the skin and the examining instrument. Other favorite sites for the oedema are the sacral and sternal regions. Occasionally sharply defined oedematous patches may be observed, particularly on the arms.
The exercise attendant upon the physical examination will probably cause a rather marked cardiac palpitation. The pulse is usually rapid and its rate is markedly affected by the slightest exertion. The systolic pressure is low.
The anaesthesia noted in the lower extremities soon tends to show itself about the back of the hands and the finger tips, so that it may be difficult for the patient to button his coat. There is also weakness of the grip. The temperature is normal and the mind is entirely clear. The results from a blood examination are practically negative, although later on there is the blood picture of a secondary anaemia.
In cases where the oedema is more marked and generalized and when pericardial or other effusions are developing we find a diminution in the amount of urine, but with an absence of albuminuria.
Later the case may show a dropsical condition more or less resembling nephritis, but with only slight scrotal oedema. At the same time there will be found a dilatation of the right heart with blowing systolic murmurs and equal spacing of the heart sounds. There may be marked pulsation of the veins of the neck. At this time the patellar reflex may be diminished and the anaesthetic areas more extensive.
This condition of wet, dropsical or oedematous beriberi may be fairly rapidly succeeded by a disappearance of the oedema with, as a result, the making more striking of the muscular atrophy incident to the neuritis of the peripheral nerves. In this, the atrophic, dry or paralytic beriberi, the jongkok test is of value. With the hands over the head the patient squats down on the calves of his legs and attempts to rise—something impossible for the beriberic. At this time the patellar reflex probably cannot be elicited and later on there will be found foot and wrist-drop with atrophy of muscles. With complete foot-drop, the reactions of degeneration will be found.
A combination of the dry and wet types of beriberi is often described as the mixed type.
It must always be remembered that the course of the ordinary case of beriberi is essentially chronic, running over months or years.
Acute Pernicious Beriberi.—This is the fulminating type of beriberi in which the marked involvement of the vagus overshadows the other but less manifest phenomena of the disease. In some cases the signs of peripheral neuritis may be quite prominent before the fulminating onset of the cardiac manifestations, there being almost a total lack of disturbance of the vasomotor system. Again we may have slight if at all demonstrable motor or sensory disturbances but with marked oedema. It should be borne in mind that this development of cardiac disturbance with its fatal tendency may develop even in a case of rudimentary beriberi. It is a common experience that cases considered as mild types may, in a few hours, show cardiac involvement and terminate fatally with striking suddenness.
There is apt to be marked epigastric tenderness or even distress coming on with the onset of the acute cardiac involvement. It may be so extreme that the patient dreads the slightest palpation of his epigastrium. From a marked palpitation and praecordial distress evidences of the dilatation of the right heart become prominent. Indications of tricuspid insufficiency are seen in the pulsating jugulars and cyanosis. The cardiac dullness is greatly increased to the right and various abnormalities of sounds and rhythm may be observed. There is also dyspnoea and a sensation of constriction of the chest (beriberic corset). These are the cases which give as horrible a picture of death as one ever sees. In the final struggle for breath and praecordial agony of the last stages of decompensation in old heart lesions we have a more gradual course in a more asthenic patient. Acute pernicious beriberi may run its course in a strong, vigorous patient in a few hours. In some cases we have paralysis of the diaphragm.
Paraplegic and Rudimentary Types.—The rudimentary type has already been considered and it would be impossible to draw a line between[283] slightly developed paraplegic cases and rudimentary ones. The paraplegic cases show the weakness of feet and hands going on to wrist and foot-drop. There is also marked blunting of sensation of feet and hands which gives one the impression of ataxia when the patient tries to button his coat.

There is atrophy of muscles so that the grip of the patient is enfeebled. This partial anaesthesia also accounts for the pseudoataxic gait in which the element of muscular weakness is prominent as opposed to the vigorous heel stamping gait of the ataxic tabetic. The patient drags the toes and leans forward on a cane when walking, thus suggesting the tripod.
It is the typical steppage gait of degeneration of the lower motor neurones. It is a flaccid, atrophic paralysis of the muscles.
There is no involvement of the sphincter.
Beriberic Residual Paralysis.—Hamilton Wright has used the term beriberic residual paralysis to indicate cases which, in the course of convalescence and favorable[284] regeneration of axis-cylinders and more or less return to a normal condition, become subject to some factor lowering the vital forces and body resistance and experience a return of the beriberi manifestations. To use a common expression the patient has a set-back and the favorable progress to complete recovery is temporarily in abeyance.
Symptoms in Detail
Nervous Symptoms.—The most common symptoms are those connected with degenerations involving the peripheral nerves of the extremities. The motor nerves are more involved than the sensory ones, there being rarely complete anaesthesia, but rather a blunting of sensation as though a piece of cloth were interposed between the examining instrument and the skin. At first there is weakening of the muscle power as shown by the grip of the hand or weakness of foot muscles. In more advanced cases we may have foot and wrist-drop. Hyperaesthesia of the muscles is prominent, especially that of the calf muscles. The unsteadiness of gait is not true ataxia as the patient does not clearly show the Romberg sign. It is muscular weakness rather than incoördination.
The Argyll-Robertson pupil is absent. The gait is the steppage one of peripheral neuritis, the patient walking as if extracting one foot after the other from clinging mud. Later on, when other muscles than the foot extensors are involved, the gait becomes a shuffling one. The mind is entirely clear. The vasomotor phenomena are often marked as shown by patchy or most extensive development of oedema and serous exudates. The knee-jerk is usually absent. Fibrillary twitchings may be observed in beriberi as well as in progressive muscular atrophy. The extensors of arms and legs are more markedly affected than the flexors. The cardiac symptoms are really connected with vagal involvement.
The Cardio-respiratory Symptoms.—Owing to involvement of the vagus the inhibitory apparatus is deranged so that we have palpitation and rapid pulse rate both of which are markedly increased by the slightest exertion.
The blood pressure is below normal. Shortness of breath is the earliest feature of respiratory trouble. This may go on to marked thoracic oppression and dyspnoea.
Aphonia may be present in acute pernicious beriberi and probably indicates laryngeal palsies. Such cases are usually fatal.
Pulmonary congestion and oedema always accompany the terminal right side dilatation of the heart which is responsible for the cyanosis, pulsating jugulars and various murmurs. The pulmonic second sound is accentuated and may be reduplicated. The rhythm of the heart sounds is replaced by the equal spacing of embryo-cardia. The diaphragm may be paralyzed as may also happen to the intercostal muscles.
Digestive and Urinary Symptoms.—Those who considered beriberi as an acute infectious disease were disposed to note frequently evidences of toxaemia as manifested by nausea, vomiting and epigastric distress. As a matter of fact these symptoms only become very prominent in pernicious beriberi and may well be connected with the cardiac decompensation. However caused vomiting is of unfavorable prognostic import.
The amount of urine is markedly decreased when oedema is advancing but is[285] succeeded by a polyuria when this diminishes. If albumin should be present it is not connected with beriberi but some other condition.
Other Features.—There is nothing characteristic about the blood other than a slowly developing anaemia.
Oedema is the most striking feature of wet beriberi. When slight this oedema may only involve the pretibial-region or sternum. Circumscribed areas of oedema may be present on the upper parts of the body as neck and trunk.
Hydropericardium is the most frequent of the exudates into serous cavities. Fever is almost always absent except in epidemic dropsy.
Diagnosis
When the case is one of mixed type with the oedema, cardiac involvement and signs of peripheral neuritis the diagnosis is readily made. A diagnosis of nephritis is often given the wet type of beriberi and locomotor ataxia the dry form, by those who have not in mind the possibility of the disease existing in an oriental crew after a long voyage.
The urine in beriberi is as a rule normal and there are no peripheral nerve disorders in nephritis. Chagas has noted that a quartan form of malaria gives rise to oedema about the ankles and is often mistaken for beriberi by the physicians of the Amazon region.
The cardiac manifestations of beriberi differ from those of valvular disease in that the murmurs are muffled and there does not exist the definite areas for the location of the murmurs of the various valvular lesions. The rapid development of a pericardial effusion is also against valvular heart disease.
The absence of lancinating pains, typical Romberg sign and Argyll-Robertson pupil should differentiate from tabes.
The tripod gait of beriberi takes its name from the wide separation of feet and use, with the hands, of a cane in front. It is a steppage gait instead of the ataxic one of tabes. On account of the lack of power to raise the toes in walking, the beriberic lifts the hip and swings to one side in order to avoid scraping his toes.
In progressive muscular atrophy the palsy attacks the hand first and in a more advanced case showing the main-en-griffe there would also be deltoid involvement. Of course beriberi may show the main-en-griffe characteristic but the greater involvement of the feet with vagal phenomena differentiates.
Ship Beriberi.—A disease of importance on Scandinavian sailing ships to which the designation “ship beriberi” has been given resembles beriberi in that we have oedema particularly of the lower extremities and at times generalized so that a case would appear to be one of wet beriberi.
More or less dyspnoea and cardiac palpitation are features of the disease as of beriberi. In fact death often is the result of acute cardiac paralysis. The striking point of difference is the generally reported absence of manifestations of neuritis and Nocht in an autopsy of a case failed to find evidence of degeneration of the peripheral nerves.
Another point of distinction is that once the ship arrives in port and a diet of fresh meat and vegetables is substituted for the one of sterilized canned meats and desiccated and preserved vegetables, the patient recovers rapidly so that in one or two weeks there is no sign of the disease remaining. Beriberics improve at once when put on a curative diet but the damage done the peripheral nerves makes complete recovery a matter of weeks or months. Nocht is of the opinion that ship beriberi is closely related to scurvy as he found sore gums and haemorrhages into muscles in some of his cases. He also notes that even in true scurvy there may be cases of dropsy without the spongy gums and haemorrhages. Dropsy plus sore gums is not infrequently noted in the beriberi-like affection of the men of the French fishing fleet off the Newfoundland banks.
Schaumann believes that ship beriberi is due to an acute deficiency in phosphorus, a chronic deficiency causing beriberi. It is probable that this disease is caused by a deficiency in certain vitamines, these being destroyed in the sterilization of canned meats or by drying vegetables.
Scurvy.—It will be remembered that in scurvy, which is the classic food deficiency disease, we have spongy, swollen gums, loose teeth, oedema about ankles and, in particular, haemorrhages into skin at site of hair follicles and tumor-like haemorrhages into subcutaneous and muscular tissues. Haemorrhages into the mucous membranes are not uncommon. The heart shows marked palpitation and weakness.
The scurvy vitamine is much less stable than the beriberi one. It is contained in fresh foods only, drying destroying it.
In connection with the question of multiplicity of vitamines monkeys fed on rice will develop beriberi while if fed on a bread deficiency diet they develop scurvy.
In Mesopotamia the Indian troops suffered greatly from scurvy but not from beriberi while the British troops had many cases of beriberi. From July to December there were 11,445 cases of scurvy among the Indian forces and 104 cases of beriberi among the British. During this period the British ate white biscuits, tinned meats and horse flesh. This latter protected them from scurvy but the Indian troops would not eat the fresh meat but ate barley flour instead. The antiscorbutic vitamines are sometimes designated as water soluble C vitamines.
Rand Scurvy.—In investigating the endemic scurvy on the Rand, in South Africa, Darling noted hypertrophy and dilatation of right heart. Such cases often showed vagal degeneration. Pathologically, these cases were closely related to beriberi, but clinically, they showed spongy gums, and haemorrhages elsewhere. The knee-jerks were always exaggerated.
Infantile Scurvy.—As differing from infantile beriberi, we have in infantile scurvy, which is attributed to the use of sterilized milk instead of fresh milk, a tendency to separation of the epiphyses from the shafts of the bones and extreme sensitiveness to any movement particularly of the legs. A markedly anaemic and asthenic condition is also characteristic. The chief lesion is a subperiosteal blood extravasation.
Milk contains several vitamines some of which, as the growth vitamine, are, destroyed in boiling; others, however, are not destroyed until subjected to a temperature of about 120°C.
War Oedema.—In those areas of Europe where famine conditions were approached during the great war a condition of weakness and oedema was noted by many observers and to this symptom-complex various designations were applied such as war dropsy, war oedema, etc. The oedema was more marked than would be true in ordinary cases of starvation so that such factors as consumption of large amounts of water and salt in the thin soups so prominent in the dietary, plus hard work, must have been additional causes.
The oedema was most common in the feet and legs, at times extending to the thighs and trunk, and in about one-half the cases involving the face. Marked muscular weakness and alimentary disturbances were common. There was dyspnoea on slight exertion with a slow pulse, but cardiac disturbances were not features of the disease. The urine was pale, of low specific gravity and free of albumin. There was reduction of red cells and a tendency to leukopenia. These cases showed marked emaciation upon the disappearance of the dropsy. As is well known the deficiency in fats was marked in Central Europe so that it was to be expected that ocular manifestations should be frequently noted, deficiency of fat soluble A being the exciting cause of xerophthalmia. The cases tended to recovery under proper diet and hospital care.
Probably the most important conditions to consider in differentiation of beriberi are the peripheral nerve involvements caused by alcohol and arsenic.
In alcoholic neuritis there is the history of alcoholic excesses, long-standing digestive disorders and tremors of hands, lips and tongue. Chiefly characteristic, however, is the mental involvement, such cases almost always showing loss of memory and defective mental concentration.
Mental symptoms and tremors are practically absent in beriberi and we have here the marked feature of vagal involvement plus vasomotor phenomena.
In arsenical neuritis we have an early puffiness under the eyelids and pigmentation of the skin which first shows itself in areas normally pigmented. A dysenteric syndrome may also be present.
There would be less chance of confusing lead palsy as this chiefly involves the upper extremity. Punctate basophilia, lead colic and the blue line on the gums should differentiate.
In diphtheritic palsies the muscles of the soft palate are involved in more than 75% of cases. Ocular palsies are also not infrequent.
In lathyrism we have a history of the eating of the chick-pea (Lathyrus sativus) or other vetches, as may occur in times of famine. Pain in the back, weakness of the legs and symptoms of spastic paraplegia appear. The spasticity differentiates. The heart is not affected.
It may be stated that there is no laboratory diagnosis for beriberi.
Prognosis
There is no disease in which one should be more conservative in making a favorable prognosis than in beriberi. A case which seems to be progressing toward recovery may suddenly develop cardiac disturbances and die in a very short time.
We now know that a change to a beriberi-preventing diet is practically curative.
The mortality rate varies in different countries and in different epidemics, so that we have death rates varying from less than 2 per cent. to those exceeding 50 per cent. In acute pernicious beriberi the prognosis is almost surely fatal.
The epidemic of beriberi which prevailed at Manila in 1882 seems to have been attended by a great mortality, this having been as high as 60% during the early part of the outbreak.
Prophylaxis and Treatment
Prophylaxis.—It must be remembered that not only is rice, from which the neuritis-preventing vitamine has been removed by excessive milling, productive of beriberi but that the same applies to other cereals which have been similarly deprived of their vitamines.
The same result may be obtained by the employment of excessive sterilization for canning.
Fresh meat is as valuable as fresh vegetables in prophylaxis but if either kind of food be subjected to excessive heat, as is the case with tinned meats, etc., they not only do not prevent beriberi but in a negative way are beriberi-producing.
While boiled beef is heated throughout, with more or less complete destruction of vitamines, roast beef does not sustain a temperature above 70°C. in its interior, hence the greater portion of the vitamine content is present in such meat.
It is possible that moulds may deprive cereals of their vitamines so that spoiled cereals may be beriberi-producing. There have been many reports both from asylums and prisons which would indicate that the employed and the patients or prisoners lived on the same ration yet the guards or nurses failed to develop beriberi, which disease was prevalent among the inmates. Such statements rarely stand the test of investigation. The same is true of pellagra.
Many of the reported outbreaks of beriberi among those who were enjoying an abundant ration have been found to be connected with the almost exclusive consumption of expensive canned meats and vegetables.
As the beriberi vitamine is apparently important in carbohydrate metabolism, a greater ingestion of carbohydrates demands more vitamine, hence an increase in carbohydrates, without corresponding increase in vitamine-containing foods, may bring on beriberi where, before the increase in carbohydrates, there was an absence of beriberi.
In connection with the development of beriberi it must always be kept in mind that debilitating conditions such as unhygienic quarters and overexertion, as well as disease conditions (malaria, ancylostomiasis, etc.) are factors of importance. In military forces excessive drills should be stopped. The fatigue factor is to be kept in mind in this as in other food deficiency diseases.
A combination of barley, which is rich in vitamines, with the rice is important in oriental countries, thus a diet containing 6 parts barley to 4 parts rice and used in Japanese prisons, on account of its cheapness, not only prevented beriberi but cured the disease in beriberics entering prison.
There is no doubt but that legislation against rice which contains less than 0.4% of P2O5 is a valuable measure of prophylaxis. Polished rice has lost in P2O5 as well as in vitamines.
Heiser has proposed that an excessive tax be placed on polished rice with free entry for the unpolished article. The following suggestions of Vedder in connection with prophylaxis would seem to be worthy of consideration in pellagra as well as in beriberi.
1. In any institution where bread is the staple article of diet, it should be made from whole wheat flour.
2. When rice is used in any quantity, the brown, undermilled, or so-called hygienic rice should be furnished.
3. Beans, peas, or other legume, known to prevent beriberi, should be served at least once a week. Canned beans or peas should not be used.
4. Some fresh vegetable or fruit should be issued at least once a week and preferably at least twice a week.
5. Barley, a known preventive of beriberi, should be used in all soups.
6. If corn meal is the staple of diet it should be yellow meal or water-ground meal, i.e., made from the whole grain.
7. White potatoes and fresh meat, known preventives of beriberi, should be served at least once a week, and preferably once daily.
8. The too exclusive use of canned food must be carefully avoided.
McCarrison has noted the value of onions even in a diet in which protein and vitamine constituents are sufficient. The onions seem to inhibit the growth of putrefactive bacteria.
Treatment.—The most important treatment is that of the substitution of a diet containing the essential vitamines for the beriberi-producing one. In carrying this out regard must be had for the customs and tastes of the race concerned. Thus fresh beef may be excellent for some people but objectionable to others. Eggs, particularly the yolk, are very valuable as is also true of unsterilized milk. Extract of rice polishings has given splendid results in infantile beriberi but does not seem to have been as efficacious in the disease in adults. Yeast has great curative value. An extract of yeast known as marmite has achieved reputation when given in doses of 20 grains daily. Seidell has recently used an autolyzed brewers’ bottom yeast. By treating this material with Lloyds’ reagent he has extracted the vitamines so that instead of having to give 200 cc., a dose of 10 grams of the concentrated product suffices.
Malt extract is very rich in vitamines and liver seems to have a higher content than beef muscle. Fat soluble A vitamine is abundant in glandular organs but scarcely present in the beef of our markets—this is probably true of water soluble B. Heart muscle is about on a par with liver. Germinating wheat and beans seem to have special value in treatment as well as prophylaxis.
In the treatment of a case care must be had not to allow a patient with any cardiac involvement to sit up in bed as this may cause sudden death. Braddon considers atropine hypodermically as of value in cardiac types of cases.
Amyl nitrite inhalations or injections of 1% solution of nitroglycerine are indicated when there is evidence of extreme cardiac dilatation. Venesection is also to be kept in mind. Cardiac tonics are of less value than rest, diet and venesection.
In the feeding of such patients only small amounts should be given at a time to avoid epigastric distress. Again carbohydrates should be restricted as there is evidence that excess of carbohydrates as well as vitamine deficiency may be concerned in the disease. The bowels should be kept open with salines. Mineral oil tends to keep down intestinal putrefaction which is a factor of importance.
Strychnine is usually given as a routine treatment in the less acute cases. With muscular atrophy massage is of prime importance. Electrical stimulation is also usually employed. With the palsies there is great danger of contractures so that even the bed clothing should not rest upon the paralyzed feet. Even splints may be necessitated.
CHAPTER XIX
PELLAGRA
Definition and Synonyms
Definition.—For a time it seemed as if the old idea that pellagra was connected with a dietary defect, chiefly as regarded some factor in a preponderating diet of maize, had been replaced by one assigning as cause some infectious process, probably protozoal, possibly bacterial.
The important advances recently made in the study of beriberi have tended once more to swing the pendulum to the food deficiency etiology. The latest views assign to food deficiency the basic etiology, but regard some other factor, possibly an infectious one, as secondarily operative.
The disease is essentially chronic with periodic exacerbations but may run a rather acute course with a rapidly fatal termination. The trend of symptoms consists of (1) mild neurasthenic manifestations in the winter to be followed in the spring by (2) disturbances of the alimentary tract, consisting of stomatitis, burning sensations going up the oesophagus, gastric eructations and recurring diarrhoeas. (3) In addition to the neurological and alimentary tract symptoms we have the third and diagnostically the most important group, those of the cutaneous system. The pellagrous eruption is characterized by strikingly symmetrical, sharply delimited patches of erythema, resembling sunburn. The sites of preference are backs of hands, extending up the forearms, bridge of nose or neck. The neurasthenia tends to pass into a toxic psychosis or even a confusional insanity.
Synonyms.—Maidismus, Alpine Scurvy, Asturian Leprosy, Mal de la Rosa, Mal del Sole.
History and Geographical Distribution
History.—Strambio considers some of the references of Hippocrates to refer to pellagra but Castellani and Chalmers state that after searching the writings of Hippocrates they have been unable to find any references to a disease showing a resemblance to pellagra.
The first definite description of the disease is generally credited to Casal who, in 1735, described the disease as it existed in the Asturias.
In his writings he notes that the peasants lived chiefly on corn and that they rarely had fresh meat.
Casal’s paper was not published until 1762 but Thitery, who visited Spain and was shown cases of pellagra by Casal, described the disease in 1755 and gave full credit[292] to Casal for the recognition of the disease. The name of the disease was given it by Frapolli, in 1771, the derivation being from pelle—skin, and agra—rough. The disease had then existed in Italy for a considerable time.
Casal called the disease mal de la rosa.
In 1810, Marzari insisted that the two diseases, pellagra and Alpine scurvy, which had a few years previously been recognized as identical, were caused by the consumption of maize and from this time on the maize theory as to etiology has been supported in Italy.
Later on (1872 to 1909) Lombroso elaborated the maize theory of etiology and so strongly presented this view that it is impossible for us lightly to set aside the arguments of this great physician.
While the zeists, as the advocates of the maize etiology are termed, insist that pellagra made its appearance in Europe following the introduction of Indian corn, after the voyages of Columbus, there does not seem to be any evidence that pellagra ever existed among the North American Indians. In 1905 Sambon insisted that pellagra was a protozoal disease and in 1910 claimed that it was probably transmitted by a midge, Simulium reptans.
About 1907 pellagra was found to be an important disease of the Southern States of the United States and since that time the number of cases has steadily increased so that it is now estimated that there have been approximately 200,000 cases in the United States.
It is generally conceded that isolated cases of pellagra had occurred in the United States prior to 1907, but they generally were diagnosed differently.
Geographical Distribution.—In Europe it is most prevalent in Italy, Balkan States, Greece, Turkey, Spain and Portugal. In Roumania there were about 100,000 cases in 1906. The disease has decreased in incidence and virulence in Italy, there having been in 1910 only 33,869 cases, as against 104,607 cases in 1881.
The disease was first recognized in Egypt by Sandwith in 1893 and is now known to be widespread in Lower Egypt. It is rare in Upper Egypt where they live on millet instead of maize. It exists in Algiers.
It has been reported from India and the Straits Settlements and prevails extensively in the West Indian Islands as well as in Mexico and Central America.
The disease in the Southern States of the United States is of a more fatal type than elsewhere, the average mortality having been 39.10%. The death rate in the United States has fallen, thus the rate in Mississippi for the years 1914 to 1916 was only ten per cent.
At present the Italian mortality is only about 3% although formerly it was much higher.
Etiology and Epidemiology
Etiology.—Like other diseases of unknown etiology the views in this connection are innumerable.
Zeists and Anti-zeists.—It is customary to divide the adherents of the different views as to the cause of the disease into two groups, the zeists, who advocate a connection between maize or Indian corn (Zea Mays) and the disease, and the anti-zeists, who claim that corn has nothing to do with pellagra.
Food Deficiency.—Before taking up the better known considerations noted above it may be stated that many now believe that pellagra, along with beriberi and scurvy, belongs to the group of “food deficiency” diseases. Just as beriberi is caused by the absence of a neuritis-preventing substance or vitamine in the dietary, so is the symptom-complex of pellagra brought about by the absence from the dietary of some vitamine or vitamines essential to proper metabolism. There are various ideas as to the factor which eliminates the pellagra-preventing vitamines.
Some claim that in the process of milling maize the vitamine-containing outer portion (bran) has been taken off just as with beriberi-producing white rice, from which the pericarp with its neuritis-preventing vitamine has been more or less completely removed.
From analyses of milled maize and millings Funk has recently suggested that pellagra in different countries is in relation to the degree of milling. Just as with rice and maize so does excessive milling of wheat get rid of vitamines, therefore, bread made from highly milled flour is dietetically deficient.
Again, as brought out by Voegtlin, alkalis tend to destroy any remaining vitamines in such bread. The practice of using sodium bicarbonate in preparation of bread is a further factor in the food deficiency problem. With the use of baking powder or buttermilk the alkaline carbonate of soda is neutralized so that there is no destructive effect on vitamine content.
The vitamine deficiency of highly milled flour and highly milled corn meal runs parallel with the phosphorus pentoxide content of such products. Whole wheat shows about 1.1% P2O5, while highly milled flour contains only about 0.1%. Whole corn has about 0.76% P2O5, while milled corn meal has only about 0.3%. Highly milled rice has under 0.4% P2O5.
Others think that as the result of bacterial or mould diseases of the corn grain these important vitamines are destroyed. Then too, as with rice and beriberi, the prevailing idea is that while there is a striking association between a maize dietary deficient in the pellagra-preventing vitamine and the occurrence of pellagra, yet this deficiency may be supplied by other foods.
Beriberi seems rather definitely to be associated with a deficiency in the anti-neuritis vitamine, which is probably the same as water soluble B., and in pellagra-producing diets a similar deficiency may be noted. More striking however is the deficiency in fat soluble A in such diets. This vitamine is abundant in butter fat and egg yolk, articles of diet of which pellagrins are deprived.
Leaves of plants contain it in abundance, while with seeds it is present in less degree and then contained in the embryo, which latter is lost in milling. Millet contains an exceptionally large amount of fat soluble A and it is well known that in Egypt those living on millet instead of maize escape pellagra. The protein of millet[294] has a high biological value which is the reverse with that of maize. It should be noted that besides vitamine and protein deficiencies the lack of inorganic salts should be considered.
Protein Deficiency.—Animal protein is a superior protein and maize protein an inferior one. Wilson grades proteins according to their assimilability and taking meat protein as 1 he assigns to maize protein a relative value of 3.4, which means that one must consume 3.4 times as much maize protein as that of meat to obtain the necessary protein requirements. Thirty grams of animal protein daily is sufficient to maintain nitrogenous equilibrium but Wilson considers 40 as a minimum B. P. V. (Biological protein value). We should have to consume 136 grams of maize protein to obtain a B. P. value of 40. Where hard labour is required the B. P. V. should be 50 and when associated with chronic intestinal disease it should be as high as 60.
Wilson noted a B. P. V. of 23 for males in the diet which caused an outbreak of pellagra in Armenian refugees at Port Said. The diet of the pellagrous Turkish prisoners in Egypt had a B. P. V. of 33.5. It may be stated that zein, the protein of maize, is deficient in tryptophane and lysine, two important amino-acids necessary for proper nutrition. Chick apparently produced pellagra in a monkey fed on a low protein diet (Total protein 8.2 grams, of which all but 2.7 grams was from zein.). The monkey was given an abundance of accessory food substances in butter, marmite and orange juice.
Amino-acid Deficiency.—In a recent paper Goldberger and Tanner note that a low biological protein value is not necessarily indicative of a pellagra-producing diet. In a series of experiments the deficiency of vitamines did not seem to be related to pellagra production and the same was true of the mineral elements. In studying the nature of low protein biological values they were of the opinion that this rested in certain amino-acid deficiencies in the proteins consumed by the pellagrins. Benefit seemed to result from administering cystine to two cases of pellagra and in a third case there was steady improvement following the giving of both cystine and tryptophane.
It is a question whether zein, the principal protein of maize, contains any cystine.
Goldberger and his colleagues, after a careful investigation of pellagra epidemiology, decided that such facts as the complete absence of the disease among the nurses and attendants of the pellagrous insane, or among the prison guards of institutions where pellagra prevailed extensively, as well as among those caring for pellagrous orphans, indicated that a dietary factor rather than an infectious one was operative in the disease. Even where it was stated that attendants and inmates of institutions had the same dietary investigation indicated that as a matter of fact the insane and the prisoners were not as well fed as the other group. Then too the insane frequently fail to avail themselves of the food provided.
A study of the records of the Army and Navy of the United States failed to show that a single case of pellagra had ever developed among the personnel, although large numbers of the men came from pellagrous districts of the South. This exemption they thought due to the generous service ration.
In an investigation of the diet of the workingman’s family in the North and South it was found that the southern one consumed much larger quantities of starches and fats than the northern one, but less fresh meat. In the family of the cotton mill operative, a class showing a great incidence of pellagra, corn bread, flour biscuits, and fat pork were the chief articles of diet. There is a great deal of ancylostomiasis among these cotton mill people and the debilitating effect of this disease may predispose to pellagra. The general rise in the cost of food and, in particular, the disproportionate increase in price of meats over cereals, since 1907, may explain the greater incidence of the disease since that time. The wages of southern mill operators have also suffered on account of frequent periods of financial depression during the last ten years, thus causing them to buy cereals rather than meats.
Goldberger’s Experiment.—In February, 1915, Goldberger started a “pellagra squad,” consisting of 11 prisoners on a diet of wheat flour (patent), corn meal, corn grits, corn starch, polished rice, granulated sugar, cane syrup, sweet potatoes, fat fried out of salt pork, cabbage, collards, turnip greens and coffee. Baking powder was used for making biscuits and corn bread. The food value of each man’s diet averaged 2952 calories.
A control was carried out with prisoners on a normal diet. The experiment was continued until Oct. 31, 1915. Of the 11 volunteers on the excessive carbohydrate diet six developed symptoms. Loss of weight and strength and mild neurasthenia were early symptoms. Definite cutaneous manifestations appeared only after five months. The skin lesions were first noted on the scrotum, later appearing on backs of hands in two cases and back of neck in one case.
There are those who believe that the methods of preserving foods, cereal or proteid, by sterilizing at high temperatures, destroy the vitamines so essential to proper metabolism so that people who subsist extensively on canned vegetables and preserved meats, instead of fresh meats and vegetables, may develop pellagra. Evidence of this sort is obtainable in the mill villages of the Southern States of the United States where pellagra is so very prevalent.
We are now beginning to recognize that slight and vague digestive trouble may be pellagrous in nature although never going on to the development of the cutaneous, neurological and alimentary tract diagnostic triad of symptoms.
Again there would appear to be efficient resistance to pellagra in those who are in good physical condition, but when reduced by illness, or the effects of poor diet and defective hygienic surroundings, they may develop it. There are those who think that hookworm disease is an important factor in predisposing to pellagra.
Not only does alcoholism, when coexistent with pellagra, make for a bad prognosis but there are many who think that any abuse of alcohol predisposes to pellagra. Against this however is the fact that pellagra in the United States is about five times[296] as common among women as among men. It is generally recognized that pregnancy and lactation predispose to pellagra.
Pellagra in Turkish and German Prisoners.—There were (up to the close of 1919) 9257 cases of pellagra among 105,668 Turkish prisoners (1 in 11) and 79 cases among 7606 German prisoners (1 in 96). The Turkish prisoners had been on a deficient diet before capture and the diet after capture had a B. P. V. of 33.5. The labour group of the prisoners had a B. P. V. of 36.8 and the disease was much more prevalent among them than in those not working. Hammond-Searle notes that the diet of the nonworking European prisoners was probably insufficient to prevent pellagra. On the average the disease appeared among the German prisoners 4½ months after capture. They stated that while in Turkey their diet had been excellent but almost all had suffered from dysentery or malaria. In the Turkish prisoners diarrhoea was a prominent feature and Bigland suggests a possible toxin action resulting from a damaged intestinal mucosa. Stools from pellagrous Turkish prisoners showed organisms similar to B. perfringens in 90% of cases while such organisms were not found in the stools of healthy prisoners.
The Zeistic Views.—The idea which was at one time entertained that maize, whether good or bad, brought on pellagra has now been generally abandoned, owing to investigations, which proved that corn possessed a fair nutritive value and was easily assimilable, together with evidence to show that where care was taken in the maturing of the grain and the prevention of decomposition by moulds or bacteria, pellagra was either nonexistent or diminished in a district where such measures were instituted.
The statement is frequently seen that pellagra did not make its appearance in Europe until after the introduction of maize, subsequent to the discovery of the New World. There are authors who think Casal was suspicious of a maize dietary.
The zeistic views now incorporate some additional factor with the basic one of a rather exclusive maize dietary.
1. The verderame theory of Ballardini. From noting on the corn grains a covering with a greenish mould, Ballardini in 1845 advanced the view that pellagra was due to this mould and from this time on we have the so-called zeitoxic views, which hold that pellagra is caused by spoiled corn. Ceni and Fossati regard a toxin elaborated by various moulds as causative. The fungi toward which attention has been chiefly directed are Aspergillus fumigatus and A. flavescens as well as certain species of Penicillium and Mucor.
2. The Lombroso view that as a result of the action of moulds or bacteria, toxins are elaborated which, when ingested, give rise to the disease.
3. That the toxins have origin in the action of various organisms, especially B. coli, on the ingested corn, while in the intestines.
4. Recently views have been brought forward that pellagra is an anaphylactic phenomenon connected with sensitization to the maize proteins.
5. Rabitschek has brought forward a photodynamic theory which is that pellagra is due to a preponderating maize or possibly other cereal dietary which results[297] in certain photodynamic substances being introduced into the circulation. These substances become toxic under the influence of sunlight. Hirschfelder has failed to find any fluorescent body in the serum of five patients suffering with severe pellagra.
Among arguments in favor of the maize etiology of pellagra may be mentioned the following:
(a) Among the natives of Upper Egypt, where millet instead of maize is the staple cereal, pellagra is rare, while in Lower Egypt where much maize is eaten the disease is far more prevalent.
(b) While the natives of Corfu, prior to 1857, grew their own maize and ate only sound grains there was no pellagra but later, when the corn crop was less profitable, and the grain was imported from Roumania, much spoiled maize was brought in and pellagra made its appearance.
(c) Alsberg has shown that in recent years new methods of harvesting corn have become common in the Southern States of the United States. Instead of topping the corn it is cut and shocked with the result that conditions are more favorable for the spoiling of the corn. He also notes that varieties of corn are now planted which have a greater oil content, which means a larger embryo, and that it is this embryo which most easily spoils. Again he notes that much corn is now raised in Northern States where the season is shorter, so that there is a greater probability of immature corn being marketed. All of these facts might explain the recent appearance of pellagra in the U. S. and its previous nonexistence. Thomas has shown that where 30 grams of a superior protein, such as that of meat, would suffice, it would require 102 grams of corn protein, an inferior protein. This inferiority is due to a lack of assimilability of the amino-acids of corn protein. Protein deficiency is the outstanding feature of a pellagra-producing diet and in the corn protein we have one of inferior value.
The Antizeistic Views.—As a rule the advocates of nonimportance of maize in the production of pellagra hold that we are dealing with an infectious disease and that it can only come into existence by transmission from some other case.
1. The Thompson-McFadden Commission, while holding a very conservative attitude, feel that certain faecal bacteria may be the etiological factors.
2. Alessandrini believes that the causative factor may be present in certain waters.
These views are that colloidal silica in water is responsible for the disease. Voegtlin noted the great amount of aluminium in certain vegetables and suggested this as the toxic causative substance. A mixture of colloidal alumina and silica in water is supposed to be operative as well as silica alone. Against the colloidal silica hypothesis is the statement of Sandwith that the water of the Nile, the drinking water of Egypt, is low in colloidal silica content.
3. Long has suggested that amoebae may be the cause.
4. Tizzoni has incriminated a streptobacillus which he stated he found in the blood and organs of pellagrins as well as growing on maize.
Epidemiology.—As the result of very careful epidemiological studies the Thompson-McFadden Pellagra Commission came to the conclusion that there was evidence against the transmission of pellagra by ticks, lice, bedbugs, cockroaches, fleas, mosquitoes and buffalo gnats (Simulium).
They were rather disposed to consider that the disease showed a greater prevalence where the disposal of faeces was unhygienic, as in unsanitary privies, and that the existence of an efficient water sewerage system prevented pellagra. If faecal bacteria should act as infectious agents then the house fly would possibly be worthy of suspicion.
Many of the peculiarities of sex and place distribution could be explained by the stable fly, Stomoxys calcitrans, a fly which bites viciously in the district in which they worked. This fly bites only by day and is intimately associated with human dwellings so that the greater incidence of the disease in the women, who stay at home, as against an incidence five times less in the men who work in the mill during the day might be explained by Stomoxys bites.
At the same time their failure to transmit pellagra to monkeys by injections of defibrinated pellagra blood would militate against any infectious agent existing in the blood. It may be stated that Harris has claimed to have produced a disease resembling pellagra in two monkeys by injecting filtrates from emulsions of brain, skin and intestinal tract of cases dying of pellagra.
Lavinder and Francis injected 79 monkeys and 3 baboons with varying material from pellagra autopsies. Some of the animals were injected with emulsions or Berkefeld filtrates of such emulsions made from brain and cord. Other monkeys were inoculated with material from skin similarly prepared, others with stomach and mouth mucosal emulsions, and still others with intestine and faeces emulsions. Blood, urine and cerebro-spinal fluid were also injected. Feeding experiments were also carried out. With one exception, and that one only suggestive of pellagra, the experiments were negative.
Sixteen volunteers, working under Goldberger, tried to infect themselves with blood, nasopharyngeal secretions, epidermal scales, feces and urine from pellagrins. Various atria of infection were tried according to material; blood by intramuscular injection, excreta by mouth. After a period of six months all the subjects of the experiments remained well. This evidence is certainly against the infectious nature of the disease.
Greater Prevalence in Women.—Now that we attach no weight to insect transmission of pellagra we have only the debilitating effects of menstruation, pregnancy and lactation to explain the marked susceptibility shown by women of from seventeen to forty years of age.[299] Before and beyond these ages the incidence in males and females is about the same.
Before Goldberger began his experiments he was struck by the relation poverty had to pellagra epidemiology, and as diet is the chief element differentiating poverty and affluence, he chose this line of research with the results recorded under etiology. His explanation of the greater incidence in adult females, especially wives and mothers, was their act of denying themselves the more desirable parts of the food.
Sandwith has noted the great frequency of pellagra in hookworm patients, thus of 300 such cases in Egypt, 46% had pellagra.
The Thompson-McFadden Commission was unable to note any evidence that would distinctly point to corn, good or bad, as giving rise to pellagra outbreaks. They did note, however, a very limited use of fresh meats.
Pathology and Morbid Anatomy
There is nothing very constant or characteristic in the pathological changes of pellagra. In the second stage the urine shows an indicanuria and the faeces an abundance of skatol. The examination of the gastric contents gives findings of anacidity and deficiency in pepsin. The HCl deficiency probably causes disturbance of pancreatic efficiency leading to mal-assimilation of fats and proteins.
The blood shows a moderate lymphocytosis but not an increase in the percentage of the large mononuclears as has been claimed by the adherents of the protozoon theory.
At autopsy we find rather marked emaciation. The wasting of all organs seems to be greater than in any other wasting disease. The skin lesions show degenerative changes in the corium with slight cellular infiltration. In the epidermis there is superficial atrophy but still some thickening in the stratum granulosum.
Warthin states that the lesions are those of a chronic intoxication. The spleen shows atrophy and in the follicles there is necrosis of germ cells as well as hyaline changes. The liver and kidneys often show fatty change. In general the changes are those of a senile character. There is atrophy of the mucosa of the small intestines and there may be small ulcers present.
The mesenteric glands are enlarged. Roaf has noted the presence of involvement of the adrenals and the Committee investigating pellagra in Turkish prisoners found a marked supra-renal inadequacy.
Macroscopically no changes are seen in the central nervous system but histologically we often note chromatolysis with bulging of borders, eccentric nucleus and disappearance of tigroid substance in various[300] nerve cells, especially those of the anterior horn, posterior ganglia, Clark’s column and Betz cells of cortex. There is an absence of chronic meningo-encephalitis and meningo-myelitis which should be present in the general type of protozoal infective lesions.
Degenerations in the posterior columns and crossed pyramidal tracts have been reported from certain autopsies.
The cell count of the cerebro-spinal fluid is normal and there is usually an absence of globulin increase with a negative Wassermann. The blood chemistry findings in pellagra appear solely to be low nonprotein nitrogen and urea values.
Symptomatology
There is probably no other disease which shows such a multiplicity of symptoms and such variations in these symptoms.
Upon questioning a patient who has developed a pellagra eruption in the spring months there is often obtained a history of more or less prolonged neurasthenic manifestations during the preceding winter, chiefly dizziness, insomnia, apprehension, occipital heaviness and muscular fatigue. There may also have been previous sensitiveness of the mouth and slight epigastric discomfort. Along with the appearance of the eruption we may have more marked alimentary tract disorders consisting of stomatitis, gastric disturbances, especially pyrosis, with a recurring diarrhoea. Upon examining the eruption we note localized, sharply delimited, strikingly symmetrical skin lesions of those parts of the body which are chiefly exposed to the sun’s rays.
This erythema is very similar to sunburn but often follows inadequate exposure to the sun and the erythema persists instead of fading. Desquamation continues for weeks or months instead of healing. The dry scaling area usually shows a striking pigmentation at the borders even after the central portions of the erythema have cleared up. The skin lesions instead of being dry and atrophic as is usual may more rarely be moist and oedematous.
From a vague neurasthenia we have now more distinct neurological manifestations such as variations in the reflexes, tremors, especially of tongue, head and upper extremities and a depressed mental state with lack of mental concentration or lapses of memory. Later on we may have a toxic psychosis in which mutism is often noted in a mental state characteristically melancholic.

A final cachexia, with dementia, loss of control of the vesical sphincter and a terminal diarrhoea, marks the end. Recurrences of clinical manifestations each spring, or possibly skipping a year, are striking features of the disease. While the skin and alimentary tract disturbances are usually in abeyance in the winter, this holds to less degree with the nervous symptoms.
The Diagnostic Triad
We may then state that in a typical case we have the diagnostic triad or pellagrous symptom-complex of (1) symmetrical sharply delimited erythemas of certain portions of the skin surface exposed to the sun with (2) alimentary tract disturbances of stomatitis, epigastric and substernal soreness and burning, with pyrosis and a recurring diarrhoea and (3) neurological manifestations in which a prodromal neurasthenia is followed by paraesthesias, in which burning sensations are prominent, at times leading to suicide by drowning, with alterations of deep reflexes, tremors and, in more advanced stages, a confusional insanity.
Burning sensations are noted in mouth, gullet and stomach as well as of the skin. Then too a burning sensation may be complained of in the area formerly the seat of a pellagrous eruption. The palms of the hands and soles of the feet often give a burning sensation.
One of the characteristic features of pellagra is the periodic recurrences in spring, with almost complete cessation of skin and alimentary tract symptoms in the winter and, again, the tendency in many cases for one group of symptoms to overshadow the symptoms which usually accompany them. These periodic recurrences may well be associated with seasonal variation in diet.
Stages in Pellagra.—For many reasons it is peculiarly difficult to recognize stages but for convenience many authors describe the disease under a prodromal, 1st, 2d and 3d stage.
These stages have reference solely to the degree of severity of the manifestations and a case may never progress beyond the 1st stage, although recurring for a number of years. Again a case may rapidly progress to the 2d stage and even run through the 3d or cachectic stage in a few months. We must not consider these stages as tending to follow in sequence as we do in connection with the stages of syphilis.
The prodromal manifestations of neurasthenia, malaise, loss of weight, loss of strength, vertigo and digestive disturbances would be suited to many other diseases, especially tuberculosis, and they are rarely recognized as belonging to pellagra until the appearance of typical skin or other symptoms brings about their association with pellagra. There is little definite information as to the period of incubation although Sandwith places it at from nine to twelve months.
In Goldberger’s cases the eruption did not appear until after five months on the experimental diet. In the study of cases of pellagra occurring among Armenian refugees, and in Turkish prisoners of war, oedema was not infrequently noted and its occurrence usually preceded the eruption.
First Stage.—In the first stage we note the alimentary tract disturbances of sodden fissured conditions at the angles of the mouth, a large indented tongue with central coating and bare glistening sides and tips, often with a shiny mucus coating these red borders and a red buccal mucosa. The fungiform papillae appear as pinhead red elevations. Later on the tongue becomes bare, red and fissured. There is often an increased flow of saliva. Aphthous ulcers are less common than in sprue. The gums are often quite tender and in cases where they are somewhat spongy and swollen, with a tendency to bleed, we note the appropriateness of “Alpine scurvy” as a synonym for pellagra.
In cases with very severe stomatitis there may be enlargement of the salivary glands. The pharynx is congested and a similar condition of the oesophagus gives rise to a burning sensation which is often described by the patient as going up the gullet from the stomach.
Gastric disturbances, especially gastralgia, pyrosis and eructations, may be pronounced. Anacidity and deficiency of pepsin are noted in gastric juice examinations. The intestinal symptoms are those of recurring diarrhoea or occasionally of a mild dysentery but in many cases there is a normal functioning of the bowels. Although the skin manifestations usually follow those of the alimentary tract they may precede them or occur simultaneously.
The Eruption.—It is usual to designate the skin lesions of the first stage as erythematous, in that they resemble a sunburn. These pellagrous eruptions may follow some source of skin irritation as well as that from exposure to the sun; thus the perianal, perineal, vulvar, and even scrotal regions may show a marked erythema from the slight irritation of the rubbing of clothes or opposite parts. Chemical irritants may also be operative.
The pellagrous erythema shows itself most commonly during the late spring or early summer. It may appear in the early spring or late summer or early fall, but only exceptionally does it occur in the winter. There are, however, alterations in the skin previously involved which can at times be noted during the winter.
The typical eruption, however, is that which shows itself on the backs of the hands or running up beyond the wrist to the lower third of the forearm. The phalanges and especially the knuckles may also show the eruption. On the face the eruption is most common over the bridge of the nose, on the cheeks and forehead. There may be spots back of the ears or on the nape of the neck. Occasionally the butterfly outline of lupus erythematosus is seen. The face may show the so-called pellagrous mask. On the neck we may have a band-like eruption[304] extending to the upper part of the sternum (Casal’s necklace) or the erythema may extend down the sternum (cravat).

Very important were the observations of Goldberger that in his six experimental cases the eruption first showed itself as a symmetrical involvement of the sides of the scrotum.
On the feet the dorsal eruption does not usually go above the malleoli and rarely involves the dorsal surfaces of the external toes although rather commonly affecting the great toe. In the U. S. the eruption may extend up the front and back of the leg (boot). The soles of the feet and palms of the hands are not infrequently involved in American cases as is also true of the tip of the elbow.
The eruption on the elbows rarely occurs until the patient takes to his bed and is probably incident to irritation over olecranon. Sandwith states that the skin lesions in Egypt are more widespread than those seen in Italy.
These skin eruptions show striking symmetry, marked delimitation from unaffected skin, with often more intense pigmentation at the border line, and they burn rather than itch.

In 1679 cases of pellagra Merk found 77% with eruption solely on backs of hands, 13% on backs of hands and neck, 8% on neck alone. The eruptions on dorsal surfaces of feet and calves of legs are chiefly seen in barefooted children. In the pellagra cases among Turkish prisoners Bigland noted an eruption on the hands in all but one of 232 cases. Rashes on the feet were noted in 111 cases and rashes on the face with bilateral symmetry were observed in 47 cases. One case showed a scrotal eruption.
The more advanced skin lesions are those of a dermatitis rather than an erythema. The affected skin is at first of a dull red color like a sunburn and later becomes reddish-brown or livid or chocolate-colored. Fox has likened the eruption to that of a carbolic acid burn.
The normal elasticity is lost and the area appears as a dry, scaly, atrophic[306] patch—it is the skin of a very old man. The moist oedematous skin lesions are far more common in the U. S. than elsewhere and may show bullae and even gangrene. Such cases may show the gauntlet desquamation.
The nervous symptoms of this stage are chiefly vertigo, headaches, which are usually occipital, and depression of spirits. Insomnia may be a marked feature. Lack of mental concentration is often noted.
Second Stage.—In the second stage we have a continuation and aggravation of the skin and alimentary tract symptoms with pronounced neurological manifestations. Tremors of the tongue and hands appear. There is great muscular weakness of the legs. Paraesthesias in great variety are common. Pain on pressure in the dorsal and lumbar regions of the back is common. The gait is more that of marked muscular weakness.
Attacks of giddiness with tendency to fall forward or backward are often reported. The deep reflexes may show variations from normal and there may be variations in the reflexes of the two sides, thus the patellar reflex on one side may be exaggerated and that on the other normal or diminished. Ankle clonus is rare. Neurological manifestations are slight in pellagrous children, the main symptoms being the cutaneous ones.
The mental state is confused and the patient shows depression and is often morose. The most common psychosis is that of simple retardation. The patient answers questions in monosyllables and in a low tone of voice after a more or less prolonged delay. Goldberger states that mental disturbances sufficient to require institutional care do not occur in more than 2 or 3% of cases.
In the second stage the urine shows rather marked indicanuria and the faeces contain an excess of skatol. Loss of weight is as marked a feature of pellagra as of tuberculosis. Well nourished pellagrins are the exceptions.
Third Stage.—With the setting in of a confusional insanity and a terminal cachexia we have the third and last stage of the disease. On account of so many of the victims of pellagra becoming inmates of insane asylums the disease is peculiarly dreaded.

Pellagra often runs a rather acute course in the U. S., the patient dying within two or three months. The usual course in Europe is one prolonged over years, with at times intermissions covering one or more years.
A form of pellagra known as typhoid pellagra often shows a high fever with symptoms more or less resembling a very toxic case of typhoid.
A mental state resembling the acute delirium of paresis may be present. Such states are often terminal. The usual course of pellagra is afebrile. Such terms[307] as pellagra sine pellagra are given to cases which may not show the skin lesions and the designation pseudopellagra has usually been used by those who insist upon limiting the name pellagra to those cases which fit in with their special etiological views so that cases clinically pellagra but in which the special etiological factor does not obtain are called pseudopellagra.
Symptoms in Detail
The cutaneous neurological and alimentary tract disturbances have each already been separately described in detail.
The Blood.—Hillman has made very careful blood examinations of a series of cases and found a variable degree of chloranaemia which however, was not a prominent feature. He notes the occasional occurrence of a leucocytosis in the course of the disease. As a rule there is a definite lymphocytosis, the average percentage of lymphocytes being 33.99. The average percentage for the large mononuclears was 2.59. The average percentage of eosinophiles was 2.73. The determinations of the coagulation time of the blood gave normal figures.
In Ridlon’s series the average red count was 4,720,000, the white count varied from 14,200 to 4200, average 8027. The polymorphonuclear percentage averaged 68.2, that of lymphocytes 21, of large mononuclears 8 and of eosinophiles 2.
Hb percentage averaged 77 and color index 0.81. The blood serum failed to give positive Wassermann reactions.
The Urine.—There is rarely any increase in albumin. The most important urinary finding is in connection with indicanuria, 96.4% of Ridlon’s cases showing this finding. As convalescence comes on indicanuria tends to lessen.
The Temperature Chart.—We expect a normal temperature in an uncomplicated case of pellagra but in typhoid pellagra and in the terminal stages of the disease a fever of from 101° to 103°F. is generally noted. Fever makes for a bad prognosis. There is nothing special about the circulatory system other than low blood pressure and a tendency to vasomotor disturbances. With the genito-urinary system other than the rather marked indicanuria, there is nothing of note.
Diagnosis
In the presence of the diagnostic triad of cutaneous, nervous and alimentary tract manifestations there is little difficulty in diagnosis but when the skin lesions are absent or only slightly developed the difficulty is great. One of the most important points in diagnosis is a history of preceding attacks.
There is no reliable laboratory test and the reports as to positive reactions following injections of maize extracts seem unreliable. Again there do not seem to be any antibodies in the serum of pellagrins which can be utilized in serological diagnosis. A primary requirement would be a suitable antigen. Competent workers have been unable to find any bacterial organism in the blood of pellagrins.
Erythema multiforme and dermatitis venenata seem to be the skin diseases most liable to cause confusion.
In old people with arterio-sclerotic changes and consequent mental symptoms there may be lesions of the hands or feet of more or less gangrenous type, which may be a real source of confusion. The lack of sharp delimitation of such lesions and the absence of the pellagrous stomatitis should differentiate.
Poison ivy dermatitis, if bilateral, may be confusing, as may also chapping of the hands.
In Italy a disease due to eating ergot-diseased rye meal and called ergotism may be a source of confusion as this disease shows gangrenous manifestations. The gangrene of ergotism is a dry one.
Sprue does not show the dermatitis, and the nervous manifestations are solely those of irritability or possibly slight neurasthenia. The sprue stool is not found in pellagra. See Diagnosis under Sprue.
Typhoid pellagra may be confused with severe typhoid fever or other acute infectious diseases or with conditions associated with coma, as diabetes or uraemia.
Prognosis
It is a risk to venture a prognosis in pellagra because cases that seem mild may suddenly become severe. The extent of the skin lesions does not parallel the severity of the case although moist or gangrenous dermatitis is usually seen only in severe cases.
When fever comes on the prognosis of the case is unfavorable and when the mental manifestations are prominent the prognosis is bad.
The Italian physicians give a more hopeful prognosis than the American ones, which is easily understood when it is considered that American mortality from pellagra is given as from 25 to 39.10%. That of Italy is certainly below 10% and recent statistics have shown a mortality of only 3%. In the U. S. the mortality is now below 10%.
Of particular importance is the question of the liability to mental trouble. Singer states that about 40% of all cases of pellagra develop mental disturbances and that this incidence is much higher in cases presenting recurrences. In Italy it is estimated that from 5 to 10% of pellagrins become permanently insane.
The earlier a case of pellagra comes under treatment the more favorable the prognosis.
In the first stage the prognosis is very good but in the second, when there is more or less involvement of the central nervous system, it is much less favorable. In the third stage, or that of the terminal cachexia with marked mental deterioration, the prognosis is extremely bad. Each recurring attack makes the condition more serious. The older the patient the more serious the prognosis.
Prophylaxis and Treatment
Prophylaxis.—There does not seem to be any satisfactory evidence as to the contagiousness of pellagra, so that any method involving isolation is not indicated.
Even if the use of spoiled corn is not productive of pellagra it is certainly advisable to prevent its sale by state regulation.
As a proper, well-balanced dietary is an important curative measure it is therefore prophylactic.
Treatment.—In a disease which characteristically shows a marked amelioration in the winter or a disappearance of symptoms for one or more years we should be very conservative in attributing improvement to any drug.
At the New York Post Graduate hospital, 17 cases were apparently cured on rest in bed and full nutritious diet. Hospital treatment, thereby removing the patients from the environment in which the disease developed, is generally conceded of the greatest benefit.
It is always recommended by the advocates of some special drug treatment that the patient be kept on a nutritious diet. Roussel in 1866 stated: “Without dietetic measures all remedies fail.”
Many authorities speak highly of arsenic in various forms as Fowler’s solution, atoxyl, salvarsan, etc. Others are equally pessimistic as to the value of arsenic in any form.
Niles is a strong advocate of hydrotherapeutic measures. He recommends the drinking of two to six glasses of tepid water daily as well as colon irrigations, cold abdominal compresses, hot packs and saline baths.
Deeks prefers to eliminate sugar and starchy food from the dietary of pellagrins for a few days at a time and to give fresh fruit juices, with broths and milk. He highly recommends dilute nitric acid, well diluted, before meals. As there is almost constantly anacidity and pepsin deficiency in the gastric juice it would seem that this condition should be treated.
It is advisable to keep the patient out of the sun and require him to take his exercise after sunset.
Dyer recommends ½ to 1 ounce gelatin daily together with the juice of two or more oranges or lemons. He prefers a diet of eggs, milk and well-cooked vegetables. He also gives quinine hydrobromate in 3 grain doses 3 times daily.
Psychotherapy seems to be of importance in the treatment of pellagra.
Lavinder says that many people have pellagra because they have some other condition and when this is cured the pellagra is also cured.
In truth, pellagra is very rarely a primary condition. We must then give careful attention to the predisposing causes which may not only be ancylostomiasis, alcoholism, or malaria, but, as well, various gynaecological or alimentary tract disorders.
With the colloidal silica etiology in view Allesandrino has recommended sodium citrate in treatment.
Goldberger has cited the following as showing the influence of diet:
In an orphan asylum with 211 orphans, 68, or 32%, had pellagra. These children were divided into 3 groups and given different rations, those under six years of age receiving milk and eggs, while those over twelve years were given meat, as they assisted in the work of the institution. The children between six and twelve lived practically on a vegetarian diet in which corn products and syrup preponderated with deficiency of legumes. Of 25 young children only 2 showed pellagra, and there was but 1 case in the 66 children over twelve years of age while the 120 between six and twelve gave 65 cases or 52%.
As the result of increasing the milk supply, so that every child under twelve years got a pint daily, also at least one egg daily, together with an increase in the use of beans and peas, as well as fresh meat, the disease was entirely eradicated. The corn elements of the diet were reduced but not excluded. There was increase in proteins and a decrease of carbohydrates.
As to the diet in pellagra Niles recommends the exclusion of all maize articles of diet. He recommends meat, eggs, milk or buttermilk with peas and beans. When intestinal symptoms are severe he gives barley gruel, rice-water, thick broths and dry meat powders. As a drug treatment for diarrhoea he uses bismuth beta-naphthol.
Babcock, recognizing the importance of the treatment of the pellagrous neurasthenia, recommends the Weir-Mitchell plan of prolonged rest in bed, nutrition, hydrotherapy and hygienic measures. “Fat and blood” should be our aims and he notes the value of cacodylate of soda in increasing fat. He also refers to the susceptibility to suggestion of pellagrins and is an advocate of psychotherapy.
Having in mind the vitamine deficiency view Voegtlin has treated cases of pellagra with extracts of substances rich in vitamines. Extracts prepared from fresh ox liver and fresh hog thymus caused definite improvement in pellagrins so treated while extracts of yeast and rice polishings seemed to be without value. It will be remembered that the glands of animals are rich in fat soluble A. For the burning of the erythema Niles recommends a lotion of calamine (4 drams), powdered zinc oxide (3 drams), in 1 pint of lime water. As regards climatic treatment the same authority believes that a colder climate is indicated and that a patient with pellagra should avoid hot weather for a year after all symptoms have disappeared.
CHAPTER XX
SPRUE
Definition and Synonyms
Definition.—Under the designation sprue we have a form of chronic diarrhoea characterized by periods of improvement alternating with a return to the previous condition. The disease is afebrile, of insidious onset and first manifests itself by soreness of the buccal mucosa and vague digestive disturbances.
The soreness of mouth and gullet is soon followed by erosions, especially at the site of the posterior molars, and a bare raw tongue. Exceedingly characteristic are the voluminous, frothy stools which are evacuated chiefly in the morning hours. The patient becomes weak, emaciated, irritable and of an earthy pallor.
The disease chiefly affects Europeans who have lived in Southern China, Cochin China and Java, and unless treated early tends to progress to a fatal termination.
Synonyms.—The word sprue is a corruption of the Dutch term “spruw” used to designate this tropical aphtha or aphthous stomatitis. The name psilosis, meaning bare, was suggested by Thin and is the term employed in many books instead of the better recognized designation, sprue.
Other designations are: Chronic diarrhoea of the tropics, Ceylon sore mouth and Cochin China diarrhoea.
History and Geographical Distribution
History.—The French (1868-1872) described this disease under the name of chronic or endemic diarrhoea of Cochin China and noted its resemblance to Moore’s “Hill Diarrhoea.” In 1876 Normand incorrectly associated Strongyloides with the disease.
The physicians of the Dutch East Indies described the disease under the designation “spruw” and Manson in a very complete description of the disease called it “sprue,” a corruption of the Dutch name.
It is interesting to note that Hillary in 1766, described a similar disease of Barbadoes, W. I., which he called aphthoides chronica.
Geographical Distribution.—It is particularly prevalent in South China and the East Indies. India and Ceylon are also regions of the disease. In the West Indies it has been carefully studied, in Porto Rico by Ashford, and of particular interest is[313] the fact that Wood has recently insisted on the presence of sprue in the Southern States of the U. S. The Philippines and tropical Africa are also sections from which the disease is reported.
Etiology and Epidemiology
Etiology.—The cause is unknown. The disease makes its appearance chiefly in Europeans who have lived many years in the tropics and may not show itself until the patient has returned home. (In one case reported by Thin seventeen years after the return home.)
It seems to select those who are weakened by dysentery or other debilitating diseases, or who are compelled to subsist on indigestible food or to lead a life of exposure to hardships. Women in whom the menstrual flow is excessive or who are in the period of lactation seem to be especially susceptible. Some think alcoholics more susceptible. The idea has been advanced that the abuse of calomel has been a factor and this view is one to be given weight because it is well recognized that at the present there is much less sprue than formerly and with this there has been a more rational use of calomel. The excessive use of highly seasoned food, so common with Europeans in the tropics, may have an influence.
Some have thought that sprue was the manifestation of a tropical pancreas; at first congestion and later exhaustion of its function. The character of the stools lends support to this view.
At one time it was thought that Strongyloides stercoralis was the cause; this idea had its origin in the finding of these larvae in the stools of a patient with Cochin China diarrhoea.
Certain authors have considered bacteria giving a granulose staining reaction as the cause while others have thought cocci to be concerned.
Kohlbrugge found organisms resembling Oidium albicans in the intestines, oesophagus and tongue. He found similar organisms in the stools and tongue scrapings of cases of sprue. Beneke found bacilli in the tongue, oesophagus and intestines and considered these as causative, regarding the thrush-like membranous deposit as connected with the cachectic state and not causative.
Bahr is inclined to believe that Monilia albicans (Oidium albicans) is the cause, as he found these saccharomycetes in the deep layers of the tongue, in the mucoid coating of the intestines and in the deposit in the oesophagus. He thinks it the ordinary thrush species which may take on greater virulence in the tropics. Ashford states that he has found a species of Monilia, different from that of thrush, almost constantly in tongue scrapings and stools of sprue cases and he regards this species as the cause of sprue. He states that this organism is common in Porto Rico bread and thinks it possible that the disease is transmitted in this way. It has been called Parasaccharomyces ashfordi. It is a round yeast, 4 to 7 microns in diameter. Wood has recently expressed the view that sprue is not infrequently mistaken for pellagra in the Southern United States.
Castellani, in a study of moulds of the genus Monilia in sprue stools, holds them responsible for the excessive gas production, although not the cause of the disease. Various protozoa, as amoebae and spirochaetes, have been considered as possible causes.
While there does not seem to be any vitamine deficiency implicated yet there is disordered assimilation, which may be due to alimentary tract infection or to insufficiency of pancreatic functioning. It has been suggested that secretin deficiency is the essential disturbance.
Epidemiology.—The disease is rare in natives and is entirely endemic. Some authorities have suggested a greater frequency of the disease in those intimately exposed to a case, as in husband and wife or the members of a family.
Sprue is usually a disease of mature life and affects women more frequently than men. While climate cannot be considered as causing sprue yet the effects of hot climates in producing exhaustion states in Europeans must be borne in mind. The sprue patient should always leave a tropical climate.
Pathology and Morbid Anatomy
The changes in the alimentary tract apparently originate in the structures lying beneath the epithelial coverings, thus indicating that the toxic material acts through the blood rather than as a surface irritant to the mucosa. At first there is congestion of the underlying connective tissue with a round cell infiltration. Later on the epithelial covering of the alimentary tract suffers and auto-intoxication, as evidenced by indicanuria, becomes operative.
At autopsy the subcutaneous fat is found to have almost disappeared. The intestines, especially the ileum, show marked thinning, this atrophy especially affecting the mucosa, the surface of which is covered by a layer of dirty gray mucus. The submucosa generally shows connective-tissue increase. The gut is pale and diaphanous. The solitary follicles may show as small cysts filled with a gelatinous material or as ulcers.
The liver is markedly atrophied. The mesenteric glands are usually enlarged. The pancreas may show cirrhotic changes.
Symptomatology
A Typical Case.—It is very difficult to obtain definite information as to the onset which is characteristically insidious.
There is usually first noted a sensitiveness of the buccal mucosa so that alcoholic drinks and acid or highly seasoned food cannot be taken without marked discomfort. A sense of fulness or distention in the epigastric region is often an early symptom. Frequently there is a history of a rather intractable morning diarrhoea which may alternate with periods of constipation.
The diarrhoeal movements are remarkably copious and soon change from bile-colored, liquid evacuations to the characteristic putty-colored, pultaceous, gas[315] bubble permeated, offensive stool of sprue. While the patient experiences a sense of relief from the evacuation of the fermenting mass yet there is at times an excoriation about the anus which may cause pain when at stool. Neuralgic pains of the region of the anus may be present late in the disease.
When examined microscopically the stools are found to show much fat, yeasts and undigested food. The fats are chiefly in the form of neutral fats and fatty acids rather than as soaps. The reaction is acid. Nausea and vomiting, especially about noon, may be complained of.
While the characteristic stools best show the full development of the disease there are also changes noted in tongue and buccal mucosa. Following the marked sensitiveness of the mouth above noted there soon appears a redness of the sides and tip of the tongue with a glistening coating of the surface. Small vesicles later becoming superficial erosions develop along the tongue borders, frenum and buccal mucosa.
There is also congestion and swelling of the fungiform papillae.
Very characteristic are ulcers at the site of the rear molars (Crombie’s ulcers). Later on the tongue becomes bare, fissured and even glazed, as if varnished.
The gullet may be raw and very sensitive. The appetite is apt to be capricious and the patient may be very intractable, insisting upon dietary indiscretions which he knows will aggravate his condition. There is a progressive loss of strength, weight and energy. The liver progressively diminishes in size but is difficult to map out owing to the bulging, dough-like abdominal contents. The urine is usually free of albumen but shows marked indicanuria. Sprue is characteristically afebrile.
Anaemia becomes marked, the red cells going as low at times as under 2,000,000, per cmm. and the Hb. percentage less markedly reduced (color index above 1). The polymorphonuclears are reduced in percentage.
There is a tendency to depression and irritability.
The period during which sprue runs its course is very variable. Some cases drag on for ten or twelve years while others may be subacute in type, death ensuing within a year or two.
In addition to the typical or complete sprue described above Bahr would add: (1) Incomplete sprue, in which with typical stools there is no abnormal appearance of the tongue, and (2) Tongue sprue, in which with characteristic mouth involvement there is absence of the sprue stool.
Symptoms in Detail
The Stomatitis.—At first we have a disagreeable bitter taste in an unusually sensitive mouth. Later there develop superficial ulcers along the sides and frenum of the tongue, which subsequently involve the buccal mucosa. The gums may be quite tender and saliva dribble from the mouth.
In the later stages the tongue becomes bare, red, fissured and glazed.
The Stools.—Commencing as early morning diarrhoea, with at times alternating constipation, there gradually sets in that which makes for a diagnosis of sprue—putty-colored, fermenting, offensive stools which are extraordinarily copious.
They are also very fatty and of acid reaction. They show a proteid loss as well as lack of fat absorption.
The Blood Findings.—There is a marked secondary anaemia with great reduction in red cells and Hb. percentage.
The color index averages higher than normal and with the poikilocytosis resembles the blood picture of an atypical pernicious anaemia. Nucleated reds are rarely found. The eosinophiles are reduced in percentage. The polymorphonuclears often show a great number of nodes, as 7 or 8 instead of the ordinary three.
There is a mononuclear increase with polymorphonuclear reduction. The white count is somewhat below normal—4000 to 6000.
Other Features of the Disease.—The liver is notably diminished in size. The urine shows indicanuria. The patient has a dry earthy skin and may show oedema about ankles.
Mentally there is lack of concentration with marked irritability and moroseness. Tetany has been reported as occurring rarely in very severe cases. The abdomen is doughy and the temperature in the later stages tends to become subnormal.
Diagnosis
Thrush is characterized by the membranous coating which microscopically shows the fungus. It also is chiefly a disease of children and those who live under wretched hygienic conditions and with insufficient food. The characteristic stools are absent.
Pellagra.—The stomatitis, diarrhoea and mental irritability are very similar in the two diseases. There is, however, absence of the sprue stools in pellagra and the periodical recurrence and skin manifestations of pellagra are absent in sprue.
Wood thinks that in the absence of any evidences of organic nervous disease in sprue we have an important differentiation as he finds that pellagra has as great a tendency to invade the nervous system as has syphilis. Salivation is marked in pellagra, not in sprue. The two diseases, however, are best differentiated by the darker, more fluid, less copious stool of pellagra as contrasted with the copious, light colored stool of sprue. Stools containing great amounts of undigested fat are most characteristic of sprue; fat absorption in pellagra is about normal (95%) while in sprue it is only about 75%.
Syphilis with its buccal mucous patches or geographical tongue may be mistaken for tongue sprue.
Hill Diarrhoea.—Many authorities do not consider this as a disease distinct from sprue. The English, however, note the features of its occurrence only at high altitudes; thus persons going to Simla suffer from hill diarrhoea but upon their return to the sea level the disease[317] disappears. The characteristic features of hill diarrhoea or Simla trot, as it is often called, are the passage of from 2 to 6 watery, whitish stools in the early morning hours. The patient is usually free from diarrhoea in the afternoon. The color may resemble that of freshly made whitewash, hence diarrhoea alba.
At first it is only the annoyance that is complained of but later on the appetite is lost and the patient becomes weak.
There is an absence of the sprue mouth. The laboratory diagnosis, other than the finding of excess of fatty acids, soaps, undigested food remnants and yeasts is unimportant.
Prognosis
While the disease responds to treatment in those who are not too far advanced yet it always should be considered a serious affection. The chances of a complete restoration to health are better for those who can leave the tropics and reside permanently elsewhere.
Treatment
It is essential that the patient possess the will power to carry out the course of treatment; the clothing should be of wool to prevent chilling and the patient should remain in bed until his condition has decidedly improved.
The Milk Treatment.—A preliminary dose of castor oil is given and when this acts the patient should begin taking milk as the sole food. At first about 4 pints of skimmed milk are given daily. The milk should be given in two-hour feedings, well warmed and taken through a glass tube or with a teaspoon—it should not be drunk. As the stools become less frothy the amount of milk is increased so that the patient takes from 6 to 7 pints daily. Milk should be the sole food for six weeks from the time the stools become solid and the mouth symptoms disappear. Rele prefers buttermilk to skimmed milk. Eggs are usually well borne after the milk course. Stale bread or toast is cautiously added and then some fish or chicken.
At times the patient seems benefited by giving a meat treatment day once or twice a week during the course of the milk treatment.
Meat Treatment.—If the patient is very ill it may be advisable, after the preliminary dose of castor oil, to give meat juice obtained by expressing the juice from slightly broiled meat, about 2 teaspoonfuls every half hour. If possible however one starts in with the meat cure, which is about 4 ounces of a lightly broiled chopped-up beefsteak, every four hours. Raw meat is usually given in this treatment but there is danger of T. saginata infection.
At least 4 pints of warm water should be taken daily but not at the same time the patient eats the meat. Rest in bed and the avoidance of chilling are important measures. In all food treatments we should avoid forcing the patient to eat—it is better to give food only when the patient desires it.
Some prefer to alternate the milk treatment with the meat one.
Fruit Treatment.—The patient is allowed fruit in great abundance. Strawberries, peaches, grapes, ripe gooseberries and fully ripe bananas are usually recommended. Papayas are particularly well suited. Pomegranates are also highly recommended. Sour or fibrous fruits should be avoided. Strawberries and milk are highly advocated. Cooked strawberries or other cooked fruits do not benefit the patient, the curative principle being apparently destroyed by heating. At all times alcoholic drinks and highly spiced foods should be avoided.
The only drug that has been advocated to any extent is yellow santonin, in doses of 5 grains, night and morning. It is very doubtful if any drug treatment is of the least value.
LeDantec, with the elimination of the granulose bacteria in mind, has recommended the cutting off of carbohydrates and the giving of a strictly albuminous diet. Subsequently he gives lactic acid producers as contained in Bacillus bulgaricus preparations.
Schmitter has recommended emetine in the treatment of sprue, but Ashford has found this drug, as well as santonin, of negative value. Brown has had success in treating a case of sprue with pancreatin, 30 grains daily. Since then he has had marked success in three other cases. He now combines the pancreatic extract with calcium carbonate.
In connection with Ashford’s work with a specific Monilia, M. psilosis, cases of sprue have been treated with vaccines made from this organism.
An autolysate of the cultures is sterilized at 56°C. for an hour and then centrifugalized. A one per cent. suspension of the sediment is used for injection increasing from about 0.1 cc. to 1 cc. at weekly intervals. Five or six injections are given.
It is stated that the symptoms at the start of the treatment are aggravated.
SECTION IV
HELMINTHIC INFECTIONS
CHAPTER XXI
ANCYLOSTOMIASIS
History and Geographical Distribution
History.—It is very probable that hookworm disease existed in Egypt in the remote past and it has been claimed that a disease mentioned in the Ebers Papyrus was of that nature.
Goeze found a hookworm in a badger in 1782. He named the parasite Ascaris criniformis. Froelich, in 1789, found hookworms in the fox and named them hookworms from the hook-like ribs of the copulatory bursa. He proposed the generic name Uncinaria. Therefore Uncinaria belongs to the hookworms of the fox and is not valid for any human species.
In 1838, Dubini noted that these worms were generally found in very anaemic cases and that the mucosa of the duodenum or jejunum frequently showed punctate haemorrhages. On account of the four ventral teeth projecting from the mouth he gave it the name Agchylostoma or correctly Ancylostoma.
In 1854 Griesinger, as a result of frequently noting the lesions produced by the worms, stated that they were the cause of Egyptian chlorosis. In 1866, Wucherer connected hookworms with a disease of Brazil called opilacao. In 1878 Grassi noted that the disease could be diagnosed by the finding of the characteristic eggs in the stools of patients.
It was the prevalence of a severe anaemia among the workmen employed in the construction of the St. Gothard tunnel, which Perroncito proved to be due to hookworm infection, that established the great importance of this parasitic disease as the cause of a severe and fatal anaemia (1879). About the same time it became generally considered that the anaemias which affected workmen in mines were of a similar nature.
That the disease was very prevalent in the Southern States of the U. S., as long ago as 1849, is shown by the writings of Duncan, who noted the frequency of anaemia, often associated with dirt eating, among the slaves. He described the oedematous[320] legs, the protuberant belly and cardiac palpitation. There were several cases reported in the U. S. from 1893-1897 but they were mainly in foreigners.
From 1895 to 1901, Stiles kept insisting that hookworm disease should be of frequent occurrence in the U. S.
A. J. Smith found several cases in persons living in Texas and recognized the fact that these hookworms were different from those of Europe. It was from a study of material from Smith and Claytor in the U. S. and, later on, from Ashford in Porto Rico, that Stiles, in 1902, reported a new genus of hookworm as existing in man. It was first named Uncinaria americana but Uncinaria, belonging to the hookworm of the fox, was not valid, so he changed the name to Necator americanus.

Geographical Distribution.—The disease is rare outside the tropical and subtropical countries except in mines or tunnels where suitable conditions of warmth and moisture exist.
It is extremely prevalent in India and Egypt as well as in China and other parts of the East. It is a very important infection in Porto Rico and the Philippine Islands. It is extensively distributed in South America, especially Brazil, as well as in Central America, Mexico and the Southern States of the U. S. The inhabitants of many of the islands of the Pacific are heavily infested. Hookworm disease is common in southern Europe.
Etiology and Epidemiology
Etiology.—The hookworm infections of man come almost entirely from two parasites, Ancylostoma duodenale, the Old World species, and Necator americanus, which is generally called the New World species from its having first been reported from the U. S. by Stiles. Hookworms belong to the class Nematoda and family Strongylidae.
Quite recently Lane has reported a new species, A. ceylanicum, as having been obtained from 3 men in Bengal, after treatment. This species is the one that infects the civet cat in Ceylon. So far as we know the other human species belong solely to man.
The male hookworms are a little more than ⅓ of an inch (9 mm.) long and the females a little more than ½ inch (13 mm.) in length. The males can readily be distinguished by their posterior, umbrella-like expansion or copulatory bursa. The tail of the female is pointed. The vulva of A. duodenale is located in lower half of the ventral surface; that of N. americanus in upper half. The large, oval mouth of the Old World hookworm has four claw-like teeth on the ventral side of the buccal cavity and two knob-like teeth on the dorsal aspect. It also has a pair of ventral lancets below the four ventral teeth. One cannot make out a dorso-median tooth. In N. americanus the buccal capsule is round, smaller and the ventral teeth are replaced by chitinous plates. Dorsally there are two similar but only slightly developed lips or plates. A very prominent, conical dorso-median tooth projects into the buccal cavity. Through it passes the duct of the dorsal oesophageal gland. There are also 4 buccal lancets. The copulatory bursa of the Necator americanus is also different, being terminally bipartite and deeply cleft in the division of the dorsal ray, rather than tripartite and shallow, as with A. duodenale.
The anterior extremity of Ancylostoma bends in the same direction as the general body curve while that of Necator hooks back in an opposite direction to the body curve.
By dropping the worms, while still alive, into hot 70% alcohol they readily assume the attitudes noted above.
In general, Ancylostoma is larger and thicker than Necator.
The name hookworm was given to these nematodes from the hook-like processes of the ribs of the rays of the copulatory bursa. Dubini called the Old World parasite Agchylostoma, properly Ancylostoma, on account of the 4 formidable hook- or claw-like ventral teeth of the buccal capsule. (αγχὶλος, hook, and στομα, mouth.)
A. ceylanicum is somewhat smaller than A. duodenale and in the copulatory bursa of the male we have a deeper cleft in the dorsal ray and 2 rather long tips to each branch instead of the shallow cleft and 3 stumpy processes of the 2 branches as in A. duodenale.
Life History.—The delicate-shelled eggs pass out in the faeces, and in one or two days a rhabditiform embryo (200 × 14 microns) is produced. The mouth cavity of the embryo is about as deep as the diameter of the embryo at the posterior end of the mouth cavity; that of Strongyloides is only about one-half as deep as the diameter.

Fig. 89.—1a, Copulatory bursa of Necator americanus, showing the deep cleft dividing the branches of the dorsal ray and the bipartite tips of the branches; also showing the fusion of the spicules to terminate in a single barb. Scale 1/10 mm. 1b, Branches of dorsal ray magnified. 2a, The buccal capsule of N. americanus. 2b, The same magnified. 3a, Copulatory bursa of Ancylostoma duodenale, showing shallow clefts between branches of the dorsal ray and the tridigitate termination. Spicules hair-like. 3b, The dorsal ray magnified. 4a, The buccal capsule of A. duodenale, showing the much larger mouth opening and the prominent hook-like ventral teeth. 4b, The same magnified. 5a, Egg of N. americanus. 5b, Egg of A. duodenale. 6a, Rhabditiform larva of Strongyloides as seen in fresh faeces. 6b, Rhabditiform larva of hookworm in faeces eight to twelve hours after passage of stool. From Stitt.
As a practical point, the anaerobic conditions in the intestines seem to prevent development of the hookworm ova or at any rate the absence of the oxygen, so necessary for the segmentations preliminary to the formation of the embryo, prevents it. Therefore hookworm ova in freshly passed faeces never show other than commencing segmentation while development of the larvae of Strongyloides takes place in the intestines, so that in freshly passed faeces we find, generally, actively moving larvae or at least eggs containing fully developed embryos. Hookworm ova very rarely show more than 4 segments or exceptionally 8 segments in the freshly passed egg.
In the presence of oxygen these ova rapidly develop into larvae, particularly at a temperature of about 27°C. Beyond 37°C. and below 14°C. development does not seem to take place.
The rhabditiform larvae grow rapidly and by the 3rd day are about 300 microns[323] long and undergo a primary moulting. By the 5th day the bulb-like swellings disappear and the larva becomes possessed of a straight oesophagus, thereby becoming a strongyloid larva. It then undergoes a 2nd ecdysis or moulting, but instead of casting off this old covering, it retains it as a protecting sheath. The full grown larva is about 550 by 24 microns. At this time it ceases to take food but can move actively in its sheath so that it can crawl up blades of grass or vertical sides of mines. They can live in this state for months, when moisture and shade are present, but are rapidly killed by drying. Before becoming encysted hookworm larvae are readily destroyed by the action of the sun or chemicals or even by dilution of the faeces, especially with urine. Cort and others have found it a common occurrence for mature larvae to lose their sheaths while living in the soil, and to continue their lives in the unsheathed state. The proportion losing their sheaths varies from 52 to 98%.
This is the infecting stage in which the larvae bore their way into the skin, which is the usual method of infection, or, occasionally, by entering the mouth on vegetables or otherwise.
Looss thought that they entered the skin by way of the hair follicles but the idea now is that they can bore into any part of the skin. It only requires a few minutes for the larvae to enter the skin. From the subcutaneous tissues they effect an entrance into lymphatics or veins, go to the right heart, thence to lungs. From the alveolar capillaries they pass into the pulmonary alveoli, thence up the bronchi and trachea, to pass out of the larynx and then down the oesophagus to the stomach. The larva loses its protecting sheath in the stomach and in a few days develops a provisional buccal capsule.
By the end of the 2nd week, after another ecdysis, the larvae have grown to be about 2 mm. long and 130 microns broad and in about 4 weeks become adults, usually in the jejunum, where, after fertilization of the females by the males, the giving off of eggs begins. The adults attach themselves to the mucosa of the intestine, feeding on the deeper structures of the mucosa, or on the tissues of the submucosa. Sambon believes that the larvae can work their way into the jejunum without going there by way of the trachea and oesophagus.
By providing an exit to the trachea, Fülleborn demonstrated that in dogs, infected with the dog hookworm, great numbers of larvae poured out of the trachea. In other dogs he stitched the oesophagus to the skin and noted larvae coming out of these openings. In these dogs, with the ordinary channel obstructed, infection did occur with, however, only a few worms, thus showing the truth of Sambon’s views but at the same time demonstrating the unimportance of such a route of infection.
The mouth cavity of the embryo is about as deep as the diameter of the embryo at the posterior end of the mouth cavity, that of Strongyloides is only about one-half as deep as the diameter. The genital anlage of Strongyloides is much larger than that of Ancylostoma.
Epidemiology.—When faeces containing hookworm eggs are deposited where conditions of moisture, warmth and shade exist, they develop into the infecting stage, which is the nonfeeding but motile larva inside the cuticle formed by the second moulting. While eggs and[324] younger larvae are killed rapidly, the encysted larvae withstand drying for considerable periods.

Stiles notes that the more favorable conditions for development are in a porous, sandy soil rather than in a clay one. Where a sewerage system exists there is very little danger of the spread of hookworm disease and the same is true where there is proper disposal of the faeces by burning, boiling or treatment in a septic tank. In rural districts, however, where the stool is often deposited in the shade and retirement of a clump of trees, the soil becomes infested with myriads of larvae, so that one standing with bare feet on such a spot easily becomes infected. It is for this reason that shoes are of protective value. In infected mines with temperatures below 22°C. infection is rare (6%); from 22°C. to 25°C. more common (16.6%), and above 25°C., it may reach high figures (61%).
Those of the negro race do not suffer from the infection as do the whites. They appear to have an immunity but serve as carriers of the disease. There is difference of opinion as to the length of time the parasites may live in man in the absence of reinfection. Some consider this period one of a few months, others of two or three years. We can certainly consider that a case leaving an infested region will get rid of his parasites within seven years.
Pathology
The site of entrance of the larvae is characterized by a dermatitis which is often called “ground itch” or “foot itch” by reason of its frequent location in the foot which has come in contact with the faeces-polluted[325] soil. The dermatitis disappears in about two weeks unless some secondary infection occurs. There are reports of pulmonary irritation which may be explained by the wandering of the larvae through the lungs.

Fig. 91.—Longitudinal section through a hookworm attached to the intestinal mucosa, about 6 hours after the death of the carrier. A portion of the submucous coat is drawn into the buccal cavity and trails along cord-like into the oesophagus, in which 4 small tissue nuclei are still discernible. Section 0.01 mm. thick. (From Mense.)
Pronounced anaemia with yellow, wax-like skin is a feature of severe cases but emaciation is rare, the subcutaneous fat still remaining. There is frequently oedema about the ankles. In the jejunum we find small haemorrhagic spots from the size of a pea to that of a half dollar. A worm may be found in the center of this spot. In sections from the tissues injured by the bite we note an infiltration of eosinophiles. The heart often shows fatty degeneration with dilatation. The liver and kidneys usually show fatty change while the spleen is generally shrunken. Sandwith noted splenic enlargement in many of his autopsies but such enlargement must have been due to other causes.
There are many views as to the manner in which the damage due to the hookworm is brought about. Some think it by bacterial infections[326] occurring through the wounds made by the worms, others that it is due to a haemolytic toxic material excreted by the worms, while Stiles considers the ingestion of the patient’s blood important. Looss thinks it due to the gradual destruction of the intestinal mucosa from the feeding on this, and especially of the submucosa, by the worms. In their feeding the worms move from site to site. When they leave a point bleeding continues and this may account for much of the anaemia.
On the side of the blood we have at first a moderate leucocytosis which disappears with the anaemia. Eosinophilia and Hb. percentage reduction are often observed. In 3 cases I have known a fatal pernicious anaemia to develop.
Symptomatology
In a secondary anaemia, with early and marked cardiac palpitation together with epigastric tenderness and a tendency to mental retardation and physical deterioration, one should always examine the stools for hookworm eggs.
The course of the disease is decidedly insidious and indefinite and the clinical diagnosis notoriously uncertain, as shown by many reports where physicians of experience, after examining a number of persons in a mill or school and only diagnosing 2 or 3% as infected, have been astonished, upon examination of the faeces of the group, to obtain positive evidence of infection in 70 to 80% of the number examined.
For convenience, it is well to divide hookworm cases into 3 groups; 1. Where the person infected fails to show any special evidence of abnormality, the diagnosis resting almost entirely on the finding of ova in the faeces.
Such cases may show very slight reduction in haemoglobin and only admit of a certain lack of energy. The best indication that hookworm infection is doing the host injury is that after treatment they gain in weight and energy and show improvement in mental concentration.
2. Mild cases with moderate degrees of anaemia, the Hb. percentage ranging from 55 to 75. In these cases there is rather marked epigastric tenderness with frequent attacks of acid eructations. Cardiac palpitation and a tendency to shortness of breath may be quite noticeable. Headache and vertigo may be present.
3. Severe cases. In such cases we may find extreme anaemia with Hb. percentages around 35 or even as low as 15. I have always felt that one was only approximating when recording percentages of 10 or lower.
These cases are very weak and show marked cardiac palpitation and dyspnoea upon the slightest exertion. There is often dilatation of the stomach and a protuberant abdomen. The red cells may fall below 1,000,000. There is also oedema, especially about the feet and ankles. Tinnitus aurium is rather frequent.
Such cases often show depravity of appetite, the best-known craving being that for earth. Other patients crave chalk, wood, cotton, etc.

Fig. 92.—Fatal case of ancylostomiasis. Red cells 810,000. Hb. 15%. White count 6400. Eosinophiles absent. Upper part of small intestines lined with hookworms. (From U. S. Naval Medical Bulletin.)
It is in children that we have the most serious effects of the disease, there being marked stunting of the growth with a corresponding mental backwardness. Such children show marked retardation and delay in answering the question asked them and often repeat it in a drawling manner. Tested by the Binet-Simon method we may find a sixteen year old child to have the mental development of a ten year old one, but at the same time we would note that from a standpoint of physical development the child only seemed ten years old.
As the child approaches adult age we note a striking lack of sexual development and the lack of pubic hair. In girls there is delay in the onset of the menstrual periods or these may never appear.
In from 80 to 90% of cases there is a history of dermatitis, particularly of toes or feet, which is commonly called “ground itch,” “foot itch,” or “dew itch.” This is most frequent between the toes or on the inner side of the sole of the foot. The irritation is due to the penetration into the cutaneous tissues of the hookworm larvae. The itching is intense and secondary infections often occur as the result of scratching. Vesicles appear about the second day and are often ruptured by the scratching with a resulting pustular or impetiginous conditions. The skin and hair generally are dry.
As a rule the temperature is normal throughout the course of an uncomplicated case of hookworm disease. During the first week or so following a heavy infection there may be pulmonary manifestations when the larvae are migrating by way of the lungs.
In the diagnosis of a case Stiles attaches much importance to a tallow-yellow color of the alae of the nose and the forehead, as well as to the eye characteristics which are like those seen in the eye of a fish or that of an intoxicated person.
He also notes that the pupil tends to dilate instead of to contract when the patient looks at a bright light. It has seemed to me that the condition is rather one of hippus. In severe cases retinal haemorrhages may occur. There may be night blindness. Ascites may be present in advanced cases.
Symptoms in Detail
Skin Manifestations.—The dermatitis following the penetration of the larvae is most often about the toes or inner side of the sole of the foot. The skin is very dry and often a pale earthy color. A tallow-yellow tinting of the alae of the nose may be observed. The hair is dry and scanty or absent in pubic and beard regions. Oedema, especially of ankles or feet, is common.
Circulatory and Respiratory Systems.—Palpitation of the heart is early and marked. Functional murmurs are frequent in the advanced stages. Pulsation of the neck veins is also common. The pulse rate averages about 110 and the blood pressure is low. There is frequently some right side dilatation of the heart. A high pulse pressure is common in severe cases. Shortness of breath on slight exertion is the most common respiratory symptom. There are at times cough and bronchitis, probably induced by the irritation of the larvae in the pulmonary alveoli.
Digestive System.—Epigastric tenderness going to the right is very characteristic. The stomach is often dilated and the gastric juice hyperacid. As the anaemia increases the acidity diminishes. It has been suggested that the desire to neutralize[329] this acidity with an alkali is the explanation of the desire for alkali-containing earth on the part of “dirt eaters.”
Patients often are pot-bellied. Constipation is rather a common feature and the stools very rarely show macroscopic blood.
Nervous System.—Hookworm patients are not only physically tired but, as well, mentally tired. The infection in children leads to a backward mental state. Patients have very little energy or initiative and are often considered stupid and lazy. Hypochondriasis is at times noted and some severe cases become melancholic.
The Blood.—The red cell count averages in marked cases 2,500,000 to 3,000,000 red cells per cu. mm. The Hb. percentage is down in such cases to between 30 and 50. The color index is well below 1, except in certain rare cases, when the color index is that of pernicious anaemia, being above 1. These latter cases are very resistant to treatment and often show very few infecting worms notwithstanding the severity of the symptoms.
There is at times a moderate leucocytosis but as a rule the white count is approximately normal.
Eosinophilia is quite characteristic and usually ranges from 15 to 35% of the leucocytes. Eosinophilia tends to disappear as the cases become advanced.
The spleen and liver very rarely give rise to any symptoms and while albuminuria is rather common in advanced cases with oedema about the feet, yet casts are but rarely found.
Diagnosis
Clinical Diagnosis.—The diseases with which it is most likely to be confused are beriberi, chronic nephritis and malarial cachexia. Stiles notes that heavy Ascaris infections may give rather similar symptoms.
The signs of a multiple neuritis should differentiate beriberi, and the presence of casts or high blood pressure, chronic nephritis. Recently, there has been a great deal written about the danger of confusing hookworm disease and malarial cachexia, the statement being often made that splenic enlargement is a feature of ancylostomiasis. Most authorities, however, state that the spleen of ancylostomiasis is not enlarged, this point being of diagnostic value in differentiating it from malaria and kala-azar.
Laboratory Diagnosis.—As a matter of fact the diagnosis is almost invariably made by finding hookworm ova in the faeces. The eggs are oval and thin-shelled with a wide, clear, glassy zone separating the more or less segmented, granular central portion from the shell.
Formed stools are more satisfactory for examination than the liquid ones resulting from a dose of salts. Put about 2 drops of water or 1% trikresol solution in the centre of a glass slide and emulsify in it as much of the faeces as is held by the spatulate end of a wooden toothpick. A small piece of wood or a match stick will answer. These preparations can be readily examined without a cover-glass, using a ⅔ inch objective, with a 1-inch ocular.
Cultural methods give a higher percentage of success than looking for ova in the stools. Put a pile of 2 inch filter papers in the center of a Petri dish. Fill the dish with water to the level of the paper island. Smear a thick layer of faeces on the paper. The larvae hatch out and can be found by centrifuging the water.
It is usually stated that about 500 worms must be present for several months to produce symptoms. Grassi has thought that the presence of 150 eggs in 0.01 gm. faeces indicates the presence of 1,000 worms, of which 25% would be males.
There may be as many as 4,000,000 eggs in a stool. Bass has proposed the following method for the examination of faeces for ova: The faeces, which have been made fluid, should be centrifuged and the supernatant fluid containing vegetable débris poured off. The sediment contains hookworm eggs. Then pour on sediment a calcium chloride solution of sp. gr. 1.050. Again centrifuge and decant. Next add calcium chloride solution of a sp. gr. of 1.250 and centrifuge. This brings to the surface the hookworm eggs which may be pipetted off. As a rule, the finding of hookworm eggs is very easy without such a technique.

Recently we have been using Barber’s technique. Emulsify the faeces in equal parts of glycerine and saturated salt solution on a slide. The eggs rise to the surface and are easily discovered with the ⅔-inch objective. As a centrifuge method, Barber emulsifies faeces in this same mixture which brings the eggs to the surface. A wisp of cotton is placed on the surface and 3 or 4 drops of melted agar dropped on the cotton. The disc of agar is removed with the cotton, deposited on a slide and examined for entangled eggs. With operculated eggs this method does not seem to be satisfactory as the salt solution loosens the operculum and floods the contents of the shell,—thus altering the specific gravity of the egg and preventing flotation.
Lane Levitation Method.—Clayton Lane recommends a technique which he designates as the levitation method. In this procedure the concentrated sediment of a centrifuged specimen is transferred to a glass slide, where it is mixed with one cc. of water. The slide is allowed to stand for five minutes and is then immersed in water and manipulated until all coarse matter has floated free. The hookworm ova stick firmly to the slide and are not washed away. Lane reports that on an average this method results in a ten-fold concentration of ova.
In certain cases, where a microscope is not available, the diagnosis may be made by finding the worms in the stool following a thymol treatment.
Whyte has recommended the phenolphthalein test for occult blood as of value in determining the cure of ancylostomiasis. This test is so delicate that the least trace of blood from the mucosal lesion will be detected.
The presence of eosinophilia is of great assistance in diagnosis but it should be remembered that not rarely severe cases of the disease fail to show any excess of eosinophiles.
Charcot-Leyden crystals are often present in hookworm stools.
Prognosis
The disease is more serious in children than in adults, on account of its interfering with physical and mental development. The dark races do not seem to suffer as much as the white ones. Treatment is usually most successful, but in those who are debilitated by other diseases or, in those in whom the disease has assumed a pernicious anaemia tendency, the outlook is not good.
The presence of eosinophilia is of good prognostic significance as the absence of eosinophiles indicates an exhaustion of the haemopoietic system.
The disease shortens the life of the people in an infected district and makes them readily fall victims to intercurrent diseases. Various statistics give the mortality as from less than one-half of 1% to figures approximating 7%.
Prophylaxis and Treatment
Prophylaxis.—The first measure is to diagnose infections in carriers and to insist upon the treatment of such persons. The proper disposal of the fecal material from hookworm patients is the objective point in prophylaxis.
The use of some type of properly constructed privy is essential as there is nothing more favorable to the development of the hookworm larvae from eggs to infecting stage than the practice of defecating on the ground where conditions of porous, sandy soil, shade and moisture exist. Later on, such a spot teems with infecting larvae and the person stepping there with bare feet is almost sure to become infected. For this[332] reason the wearing of shoes is an important prophylactic measure. At the same time shoes are not a sure protection, as Ashford has noted infections in soldiers who wore good shoes. The fecal material, collected in a pail or tub, should preferably be burned or boiled. Otherwise it should be buried not less than 300 feet from the water supply and down hill from the same.
The best method is to use some septic tank process as the anaerobic processes of fermentation destroy the eggs.
The use of an amount of compound cresol solution equaling the fecal mass, plus urine, is of value.
Hookworm disease tends to disappear in towns or cities where there is an efficient sewerage system.
Hookworm disease is one of the most conspicuous examples of soil pollution disease.
Some authors think Ancylostoma more difficult to expel than Necator.
Treatment.—The drugs best known in treatment are thymol and chenopodium but carbon tetrachloride offers the greatest promise.
The Thymol Treatment.—Bozzolo introduced this drug in the treatment of hookworm disease in 1879. Thymol has an aromatic, thyme-like odor and a pungent taste and, while soluble in about an equal amount of alcohol, is only soluble in water in the proportion of 1 to 1100.
It is usual to prescribe the drug in 5-grain capsules or preferably in cachets, one part of thymol being triturated with an equal amount of sugar of milk. If the cachet is moistened with a little water it may be swallowed like a raw oyster.
Stiles prefers giving the treatment on Sunday so that the working days of the patient may not be lessened. By giving the patient bicarbonate of soda for a few days before the treatment it is thought that the mucus lining of the jejunum is cleared away so that the worms are more readily affected by the drug. At any rate one should give about 1 or 2 ounces of a 50% solution of Epsom salts on Saturday evening. Sodium sulphate is preferred by some.
The following morning at 6 A.M. the patient takes one-half the dose of thymol proper for his age and at 8 A.M. he takes the remaining half of the dose. At 10 A.M. he takes another dose of Epsom salts. The reason for dividing the dose of thymol is that should untoward symptoms occur after the first portion of the dose we do not give the second. Stiles now prefers to divide his dose into three portions, one to be given at 6 A.M., one at 7 A.M. and the remaining third portion at 8 A.M., followed by salts at 10 A.M. The patient should lie on the right side while taking the treatment to facilitate the passage of the drug from the often dilated stomach.
The patient should remain in bed until 12 o’clock when he may take some coffee, without milk, and crackers.
Patients must be warned to avoid anything containing fats or alcohol while undergoing treatment as fats and alcohol dissolve the thymol and tend to cause poisoning. Under no circumstances should castor oil be used. People are apt to forget that butter, milk, etc., contain the dangerous fats.
Seidell has shown that about one-third of the thymol dosage is excreted in the urine and very little by faeces. This shows absorption of the drug. It is thought some of the drug may be excreted by the lungs. Congestion of the lungs has been reported in fatal cases of thymol poisoning.
Mild symptoms of poisoning are burning in the pit of the stomach and tingling sensations of the body. More severe symptoms are those associated with cardiac weakness and respiratory distress. Coffee and strychnine are the usual remedies for thymol poisoning. Inhalation, but not swallowing, of aromatic spirits of ammonia is often of value.
The thymol dosage recommended according to the age, or rather the apparent age of the patient, is:
| Under 5 years old | 7½ grains. | |
| From 5 to 9 years old | 15 grains. | |
| From 10 to 14 years old | 30 grains. | |
| From 15 to 19 years old | 45 grains. | |
| From 20 to 59 years old | 60 grains. | |
| Above 60 years old | 30 to 45 grains. |
Total dose to be divided into 2 or 3 portions. The patient is allowed to eat only a light luncheon and supper the day of the treatment but the next day he may resume his regular meals.
As a rule most of the worms expelled by the treatment will have been passed by night of the day of treatment, although an occasional one may be passed for four or five days.
In from 25 to 50% of cases all the worms may be expelled in one treatment but it is usually necessary to give as many as 3 treatments, one on each of three Sundays.
Thymol and Beta-naphthol.—Nicol in a comparison of the efficacy of various drugs, noted that thymol in 90-grain doses, taken in 3 portions of 30 grains each, at 6, 8, and 10 A.M. expelled 98% of the worms at the first treatment and the remaining worms at the second treatment a week later. With this rather large dose he frequently observed a tendency to syncope. He used Epsom salts as a purgative.
On the other hand, while using 60 grains of beta-naphthol, given in two portions at 6 and 8 A.M., followed by salts, 86% of the worms were expelled at the first treatment and 14% with the second one. He did not observe any bad effects from beta-naphthol.
The great objection to beta-naphthol is that it is a renal irritant and may damage a kidney already diseased.
Nicol found the treatment with eucalyptus oil, 2 cc., chloroform, 3 cc. and castor oil, 30 cc. vastly inferior in anthelminthic effect to the other two treatments and liable to cause severe manifestations of nausea and syncope.
It is better to divide the dose as just stated into two portions, the second half to be given about one-half hour after the first portion. This reduces the danger from the chloroform.
Schüffner tried male fern and only obtained 7 hookworms while the next day, using thymol, 1253 hookworms were expelled. He notes that thymol is dangerous when administered to patients with acute or subacute dysentery.
In Brazil a tabloid of 5 grains beta-naphthol combined with 1 grain of phenolphthalein has been generally employed. Using phenolphthalein in this way enables them to dispense with purgation.
Oil of Chenopodium Treatment.—As the result of comparing the relative efficiency of thymol and oil of chenopodium the International Health Board Commission reported in favor of oil of chenopodium. In only 7.6% of the cases treated with chenopodium was there failure to eradicate the parasites while there was noted 23.6% of failures with thymol. The dose of oil of chenopodium recommended was 1.5 cc. given in three divided doses of O.5 cc. at 7, 8, and 9 o’clock in the morning. Two such treatments will remove 99% of worms present in a case. The Commission found the oil more efficient than an emulsion of the oil.
The low diet and preliminary dose of salts, as noted under thymol treatment, are to be recommended although the commission found various purges to have little effect on the results of treatment. At 11 o’clock give a purgative dose of magnesium sulphate.
The maximum dose of oil of chenopodium is usually given as 3 cc. but a number of deaths have followed the administration of doses of from 2 to 3 cc., so that it is better to keep within 1.5 cc.
After effects of treatment, such as dizziness, depression, unsteady gait, partial loss of consciousness, tingling of hands and feet, burning sensation in the epigastric region and nausea are more frequent with chenopodium than following thymol. The toxic symptoms may be greatly delayed and even be postponed for a day or so. A large dose of castor oil seems to be the most important measure in treating a case of chenopodium poisoning. The same methods of stimulation as noted under thymol poisoning are also indicated.
Kantor has treated a large number of cases with oil of chenopodium administered through the duodenal tube. After the bucket had passed the pylorus he introduced into the duodenum about 2 cc. of oil of chenopodium and followed this in six minutes with two (2) ounces of a warm saturated solution of magnesium sulphate. The tube is withdrawn after introducing the salts. Several copious watery stools follow in a short time.
Carbon tetrachloride in a dose of 3 cc. administered in hard gelatine capsules, is recommended by Hall for the removal of hookworms and ascarids. The drug is[335] cheaper, more effective, and, when chemically pure, safer than thymol or chenopodium. It does not depress unstriated musculature or lessen peristalsis, thus eliminating the use of purgatives, which is an item of expense in extensive hookworm campaigns. The drug is of no value in treatment of tapeworms and is as unreliable as other anthelminthics for the removal of whip-worms.
There is a rapidly growing mass of reports concerning the clinical use of carbon tetrachloride, all of which agree in confirming experimental observations regarding its effectiveness, and indicate that a standard dosage as high as 10 to 12 cc. may be safely employed.
After expelling the worms it is advisable to give the patient a tonic containing iron or arsenic. In those cases with a tendency to pernicious anaemia the arsenic treatment is better than that with iron.
In the treatment of ground itch the usual application is a zinc oxide ointment containing 10 grains of salicylic acid to the ounce.
Barlow recommends a 3% salicylic acid solution in alcohol.
CHAPTER XXII
FILARIAL INFECTIONS
General Considerations
The filarial worms are thread-like nematodes, with a thin cylindrical oesophagus, which live in various parts of the body and may or may not give rise to disease conditions. It is one of the most remarkable facts in animal parasitology that a person may harbor numerous adult filariae and myriads of embryos without in any way manifesting symptoms of the infection. In most of the filarial worms the female has a double uterus with the uterine opening near the anterior extremity.

It has been proposed to designate the filarial embryo by the term microfilaria, reserving the generic name Filaria for the adult parasite. This may be convenient for differentiation but zoölogical nomenclature does not permit different names for adults and embryos. While there have been almost 20 different filarial species reported for man there is, in some instances, doubt as to the correctness of the observation, and again, a well recognized species has at times been considered as a new species and given a new name.
From a practical standpoint we need only consider: (1) Filaria bancrofti; the adult of which lives in the lymphatic glands and vessels while the sheathed embryos (which from their appearance in the blood only at night are called Filaria nocturna) obtain access to the peripheral blood vessels.

Fig. 95.—1a, Adult female Guinea worm (Dracunculus medinensis) showing anchoring hook at posterior extremity. 1b, Cross section of female Dracunculus showing uterus filled with embryos. 1c, Striated embryos of the Guinea worm. 1d, Cyclops coronatus, the minute crustacean which serves as the intermediate host of D. medinensis. 2a-2d, Anterior and posterior extremities of L. loa. 2c, Section showing tuberculated cuticle. 2b, Male and female L. loa, natural size. 3a, Bulbous anterior extremity, Filaria bancrofti. 3b, Tail of male. 3c, Tail of female. 3d, Male and female, natural size of F. bancrofti. 4a, Tumor mass of O. volvulus laid open. 5, Mosquito showing filarial embryos in thoracic muscles (a) and in labium (b). The labella which are separated from the labium by Dutton’s membrane are seen at (c). 6(a) Embryo of F. bancrofti. (b) Embryo of L. loa showing filling of tail end with cells. 7, Microfilaria of F. bancrofti in blood. Dotted lines show location of break in cell column and V spot.
Various well-known conditions are caused by this parasite, such as elephantiasis, varicose groin glands, chyluria, etc. This infection was formerly stated to be caused by Filaria sanguinis hominis.
(2) Loa loa, the adult of which wanders about in the subcutaneous tissues, characteristically in the region of the eyes, while the sheathed[338] embryo is found in the blood during the day, hence Filaria diurna.
Calabar swellings, irregular febrile conditions and the disagreeable sensations incident to the wanderings of the worm are clinical features of this infection.
| Adults | Embryos | Remarks | |
| Filaria bancrofti | Male 40 by 0.1 mm. Female 90 by 0.28 mm. Smooth cuticle. Bulbous anterior extremity. Occupy lymphatic glands and vessels. | Sheathed, 300 by 7.5 microns. Distance from head to V spot 90 microns; to break in cells 50 microns. Tail rather straight. Terminal cells do not fill up tail end. Nocturnal periodicity in peripheral circulation. | Transmitted by mosquitoes, Culex fatigans and Stegomyia pseudo-xxx scutellaris. Causes elephantiasis, lymph scrotum, chyluria, etc. |
| Loa loa | Male 27 by 0.3 mm. Female 55 by 0.4 mm. Cuticle tuberculated. Anterior extremity like truncated cone. Wanders in subcutaneous tissues. | Sheathed, 240 × 7 microns. Distance from head to V spot 65 microns; to break in cells 40 microns. Cork-screw tail which is completely filled up with terminal cells. Diurnal periodicity in peripheral circulation. | Transmitted by species of a biting fly—Chrysops. Causes calabar swellings. Worms often visit ocular region. |
| Acanthocheilonema perstans | Male 40 by 0.07 mm. Female 75 by 0.1 mm. Cuticle smooth. Tip of tail shows 2 triangular processes. Found about root of mesentery. | Without sheaths, 200 by 5 microns. Posterior two-thirds tapers to blunt ending. Distance from head to V spot 49 microns; to break in cells 34 microns. Persists in circulation both day and night. | Transmitting agent not surely known. Mosquitoes and ticks suggested. No pathogenicity. |
| Onchocerca volvulus | Male 30 by 0.14 mm. Female usually fragmented. Possibly 75 by 0.36 mm. Cuticle striated. Found coiled up in cyst-like tumors under skin. | Without sheaths, 250 by 7.5 microns. Found in cyst-like spaces of tumors. Not in peripheral circulation. | Method of transmission unknown. Causes small cystic tumors, under skin of thorax especially. |
| Dracunculus medinensis | Male from Leiper’s monkey 22 mm. Female 80 to 90 cm. long by 1.6 mm. wide. Smooth white body. Anchoring hook at tail end. Female lives in subcutaneous tissue of lower extremity. | Without sheaths. 600 × 20 microns. Long slender tail. Cuticle striated. Extruded from break in skin of patient. | Embryos swallowed by Cyclops. Man drinks water containing Cyclops. |
(3) Onchocerca volvulus. The males and females of this parasite are found coiled up in channeled connective tissue tumors of the subcutaneous tissues.
The sheathless embryos have been surely found only within these tumors and not in the blood.
(4) Acanthocheilonema perstans. This parasite does not seem to give rise to clinical manifestations except possibly to cause an irregular fever.
The adult is found in the retroperitoneal connective tissue or fat, while the sheathless, blunt-tailed embryo is found in the blood, both by day and night, hence perstans. The adult forms are found in the tissues behind the abdominal aorta and at the attachment of the mesentery.
(5) Dracunculus medinensis. The female of this parasite, about 36 inches long and 1/15 inch in diameter, travels to the subcutaneous tissues of the extremities and boring through the skin causes a small surface erosion.
An unimportant filarial worm which has been found only in the West Indies and British Guiana is known as Filaria demarquayi or F. ozzardi. The embryos have sharp tails and are without a sheath. The parasite is not known to produce symptoms.
History
Filaria bancrofti.—While elephantiasis was frequently described by ancient writers yet the confusion between Elephantiasis Graecorum, a term applied to leprosy, and Elephantiasis Arabum, or the filarial condition, made the question of the nature of the skin thickenings very indefinite.
The thickenings due to leprosy and those connected with filariasis were separated clinically by observers during the 17th and 18th centuries, Hilary, in 1750, having accurately described the progress of that form of elephantiasis connected with elephantoid fever and lymphangitis. In 1863 Demarquay discovered filarial embryos in the exudate of a chylous hydrocele and three years later Wucherer, in Brazil, found similar nematode larvae in the urine of a case of haematochyluria. Commencing with the year 1863 Lewis carried on a series of investigations in Calcutta in which he found these embryos not only in the urine of patients with chyluria but as well in the lymph and blood of those affected with elephantiasis. He called the parasite Filaria sanguinis hominis, a name still frequently employed by medical writers.
In 1876 Bancroft, in Australia, discovered the adult filarial worms in a lymphatic abscess, hence the name Filaria bancrofti. In 1878 Manson, in China, demonstrated the mosquito transmission of the disease as well as the phenomenon of nocturnal[340] periodicity. Manson’s idea, however, was that the fully developed embryo escaped from the body of the infected mosquito at the time of the death of the insect and that man contracted the infection in drinking water.
The investigations of Low and more recently those of Fülleborn and Bahr and others have shown that the larvae escape by way of the mosquito’s proboscis and enter the skin of man.
Loa loa.—The knowledge of a filarial infection of the region of the eye seems to date from the time of Magellan. Although the disease is now confined to the west coast of Africa, cases were reported from the West Indies by Mongin and Bajou during the 18th century. These cases were in slaves who had contracted the infection in Africa.

Fig. 96.—Section of Stegomyia pseudoscutellaris, showing filariae in thorax on tenth day of development, travelling forwards into proboscis. By permission from Manson’s Tropical Diseases.
In 1891 Manson noted the presence of the larval forms which showed a diurnal periodicity in the peripheral blood.
Dracunculus medinensis.—Ancient Egyptian writings would indicate that the disease was well known in those times. It is believed that the[341] fiery serpent of the wilderness, which afflicted the Children of Israel, was an infection of this sort.
The prevalence of dracontiasis, as the infection is generally termed, in Arabia, was well known to the Greeks and Romans.
Fedschenko, in 1870, noted the transmission of the disease by species of Cyclops.
Onchocerca volvulus was first discovered in 1893, in peculiar tumors of the natives of the Gold Coast.

Acanthocheilonema perstans was first found by Manson, in 1891, in the blood of natives of the Congo.
Daniels also found these embryos, along with those of F. demarquayi, in the blood of natives of British Guiana.
FILARIA BANCROFTI
Geographical Distribution
This parasite has been found in almost all tropical and subtropical countries. It is quite prevalent in the West Indies and has been found in some of the Southern states of the U. S. It is very common in some[342] of the South American countries as well as in Central America. The infection is widespread in Arabia, India and China. Africa, especially the West Coast, and Australia, particularly in Queensland, are parts of the world where the infection prevails.
It is especially in some of the Pacific islands, as Samoa and Fiji, that it is extraordinarily prevalent. Bahr has stated that Fijians in the proportion of 27% show filarial embryos in their blood. In 25% of these natives clinical manifestations of the disease exist but the embryos are absent from the peripheral circulation. In other words more than one-half of the population show absolute evidence of infection.
Life History
It is a well-known fact that filarial embryos may be present at night in the peripheral blood of persons not showing a single symptom of filariasis and again, in those with marked elephantiasis, varicose groin glands or chyluria there may be an entire and permanent absence of embryos in the blood. When certain mosquitoes bite persons having embryos in the blood they take into their stomachs the sheathed embryos of F. bancrofti. Flu states he has succeeded in infecting the following mosquitoes: C. fatigans, S. scutellaris, M. ludlowi and M. rossii. The most suitable carriers proved to be C. fatigans and S. scutellaris. Large numbers of larvae perish in anopheline mosquitoes.
The following developmental cycle has been demonstrated for Culex fatigans and Stegomyia pseudoscutellaris. Bahr has found that if there are too many embryos taken up by the mosquito the insect is apt to die, as the result of too heavy an infection; so that a person harboring many filarial embryos may be less dangerous than one with a smaller number. Upon reaching the stomach of the mosquito the sheath of the embryo becomes fixed in the viscid blood contents and the embryo itself by active motions is able to force itself from its sheath. This escape usually occurs within two hours but may take longer. The free embryo then bores its way through the stomach walls and within twenty-four hours has reached the thoracic muscles of the mosquito. Within forty-eight hours the embryo begins to broaden and the anterior and posterior V spots to become more prominent. About the end of the first week there commences the formation of an alimentary canal, by which time the developing larva is about 0.5 mm. long. When the larva is about 0.6 mm. long an ecdysis apparently takes place. Later on these larvae develop 3 or 4 terminal papillae and make their way to the fleshy labium of the mosquito’s proboscis. An occasional larva may enter other structures than the labium but in such case they would be unable to effect an entrance to their definitive host, man. These larvae in the proboscis are about 1.5 mm. long and about 20 microns broad.
The mosquitoes have two terminal processes, the labella, separated from the labium by a thin membranous partition called Dutton’s membrane. The larvae,[343] having completed their developmental cycle in the mosquito, which takes about three weeks, and moving down the labium, break through this membrane when it is put upon a stretch by the wide separation of the labella at the time of feeding on the part of the mosquito. It was formerly supposed that the larvae entered man through the puncture made by the biting parts of the mosquito, but Bahr has shown by experiments that they effect an entrance through the intact pores of the skin as does the ancylostome larva.
These larvae upon entering the human host reach the lymphatic vessels or glands and in this definitive host (man) the females are fertilized by the males and give off sheathed larvae from the uterine opening near the anterior end of the worm.

The sheath is simply the egg membrane which from being oval at first becomes stretched by the developing embryo to finally become a long, narrow sac encasing the fully developed embryo as it exists in man. From the lymph stream they reach the general circulation. In a case of a man with filarial embryos in his peripheral circulation, who committed suicide one morning, Manson found the embryos, in large part, contained in the vessels of the lungs. There were 675 embryos per slide in blood from the lungs for one from blood from the spleen or liver. It would thus appear that during the day, when the embryos are absent from the peripheral circulation, they retire to the lungs. In the case of the filarial embryo of persons in the Pacific Islands there does not appear to exist any periodicity. Bahr thinks this absence of nocturnal periodicity to be connected with the habits of its principal intermediary host, Stegomyia pseudoscutellaris, which feeds by day. Culex fatigans feeds at night.
With the filarial embryos found in patients in the Philippines there is also a lack of nocturnal periodicity. In the opinion of Ashburn and Craig the Philippine filarial worm is a new species, Filaria philippinensis.
Walker, however, recently examined four adult filarial worms in the Philippines and was unable to note any differences from F. bancrofti.
Pathology and Morbid Anatomy
The adult worms may exist in numbers and over long periods of time give off great numbers of embryos into the peripheral circulation without there being any evidence of disease in the patient. There[344] is apt to be at such time a marked eosinophilia. The process by which the fibrosis of lymph channels with obstruction to the flow of lymph occurs is unknown. Some think that with the pouring out of embryos inflammatory processes, bacterial or otherwise, may be set up. We know that there is a tendency for these adults to die and become calcified, in this way bringing about lymphatic obstruction.
Bahr notes the influence of adult filariae in producing an increase in connective tissue in glands and considers such glands as less resistant to bacterial infection.
Manson has an idea that some factor may cause the female to give off immature embryos, which being oval, and of considerable width, may block the lymphatics.
It has often been claimed that various cocci were the exciting factors in the lymphangitis associated with filariasis. Recently Dutcher has reported the isolation of an organism resembling B. subtilis as the cause of filarial lymphangitis (Bacillus lymphangiticus).
As the result of the lymphangitis and blocking of the channels the embryos cannot reach the peripheral circulation; hence when obstruction does occur and symptoms of lymph stasis appear, there may be an absence of embryos in the circulation.
It is now well established that patients with elephantiasis very rarely show embryos in the peripheral circulation, and this fact should be better understood because there is a tendency to negative a filarial diagnosis when embryos are absent from the peripheral circulation.
These lymph channel obstructions may at one time cause dilatations or varices and at another bring about solid oedemas of the tributary parts. The treatment will be considered under each special form of the disease. It may be stated however that salvarsan, arsenophenylglycin and other similar remedies have been without special effect in destroying the filarial worms.
Clinical Manifestations
Not only is it important to understand that elephantiasis and other manifestations of filarial infection may and usually do exist without there being embryos in the peripheral blood of the patient, but also, that a high percentage of a population may show filarial embryos in their blood and yet never or with extreme rarity show any of the signs of filarial disease. These people, with abundant embryos in their blood, usually show no disturbance of health. In the Philippines one may rarely see a case of chylocele but usually there is nothing clinical to note.
Johnson, in examining 400 people, in Charleston, S. C., found 19% with filarial embryos, yet only 5% showed any symptoms of filariasis. Croll states that 11.5% of 4000 Europeans admitted to the Brisbane Hospital (Australia) showed filarial infection but practically none had symptoms. In South Queensland cases of lymphangitis, chyluria and varicose groin glands are occasionally seen and rather frequently hydrocele and filarial abscesses. There is an absence of elephantiasis.
Elephantoid Fever
The febrile accessions that accompany the recurring attacks of lymphangitis in elephantiasis, lymph scrotum and other filarial manifestations, are very important because they may lead to errors in diagnosis.
Thus in Barbadoes, where there is no malaria, a condition in which there occurs a high fever of sudden onset with rigors and associated erysipelatous redness of leg or scrotum, accompanied by lymphangitis and painful lymphatic glands, has given a suggestion of a malarial paroxysm. The tense inflamed area, after several days, shows an exudation of lymph and the redness disappears, but with some resulting thickening of the affected tissues. Such attacks may terminate with profuse sweating.
The treatment of the condition is such as would be advisable for ordinary lymphangitis—rest in bed, elevation of the part, laxatives and local applications.
Lymph Scrotum
This condition is apt to set in with fever. The scrotal tissues are somewhat tense and reddened and may show numerous lymphatic varices which when pricked with a needle, give exit to lymph which may or may not contain filarial embryos. The lymph continues to exude for a long time. Erysipelatous manifestations are not uncommon. With recurring attacks the scrotal tissues become more and more hypertrophied and may go on to elephantiasis of the scrotum.
Ordinarily local applications with suspension of the scrotum is the proper treatment. Should the thickening increase to a great extent the blubbery tissues may be excised, care being exercised to avoid the testicles and to bring together sound tissue for the enclosing flaps. These wounds usually heal readily, although there may be delay in healing from the outpouring of lymph in cases where the flaps include diseased tissue.
Varicose Groin Glands
Swellings which come on rather slowly and insidiously may involve the inguinal or femoral groups of glands of one or both sides. The epitrochlear glands may also be involved. The skin over the enlarged,[346] rather doughy glands can be freely moved but the glands themselves are bound down to the deeper tissues. Elephantoid fever may set in associated with local manifestations of pain and redness.
If such glands are punctured with a hypodermic needle lymph, which may contain embryos, exudes. This test together with their slow disappearance on lying down and slow return on assuming the upright position should differentiate hernia. When the contents of a hernial sac are omental there is some difficulty in diagnosis. As a rule it is not advisable to interfere surgically in this filarial condition.

Fig. 99.—Varicose groin glands and elephantiasis of scrotum and penis. (From Ruge and zur Verth.)
Filarial Abscesses
As a rule injury to the adult filarial worms, which results in their death, is not followed by abscess formation but such termination may occur. These abscesses have been found deeply seated in the extremities. Wise and Minett in a careful examination of 28 such cases found evidences of adult filariae in 22 cases. In 21 of these abscesses, infections with streptococci or staphylococci were demonstrated. Very interesting also is the finding of filarial worms in deep-seated abdominal abscesses.
As regards location, these filarial abscesses were found 31 times in the pelvis of the kidney, 18 times in the epididymis, 12 times in the retro-peritoneal tissues, 25 times in the inguinal glands, 4 times in the ilio-psoas muscles and 8 times in the lymphatic vessels.
They regard the endemic funiculitis to which attention has been directed by Castellani as simply a similar process involving the tissues about the spermatic cord. The treatment of filarial abscesses is similar to that of other abscesses.
Chyluria
As the result of obstruction of the lymphatic vessels varices may form in the bladder lymphatics and, as the result of their rupture, milky urine may be passed. If the thoracic duct be occluded the urine will show an abundance of fat, while if the obstruction exists only in other[347] lymphatics, the milky fluid will be found to show but little fat. Blood is usually present in chyluria so that the urine will show an pinkish tinge.
Chylous urine coagulates rapidly and we have in such a specimen of urine, upon standing, an upper fatty layer and pinkish sediment at the bottom, with a clot between.
The sediment shows lymphocytes and at times filarial embryos. When the exudate is lymph mixed with blood the term haematolymphuria would be a better one.
Clots may form in the bladder and give rise to obstruction to the flow of urine from the bladder.
The appearance of the chyluria is often preceded by heaviness about the loins and pains in the region of the bladder.
The morning urine in such a case is apt to be clear while that passed later in the day is milky in appearance.
A feature of chyluria is its tendency to disappear and reappear so that when treating such a case one should be conservative in considering the treatment as effecting a cure.
It is difficult to understand why chyluria should be common in India and China while almost unknown in the filarial infections of the Pacific islands.
In treating a case of chyluria one should enjoin rest in bed, laxatives and a restriction of fluids and fats. Patients subject to the condition should refrain from active exercise and other conditions which might cause fatigue. Drugs are of little value.
Filarial Orchitis and Hydrocele
The condition rather resembles an attack of epididymitis. As a result of recurring attacks hydrocele develops. The fluid may be lymphous or chylous in appearance and upon microscopical examination may show filarial embryos. These filarial hydroceles seemed to be the most common manifestations of the disease as observed in the Philippines. These hydroceles or chyloceles do not become very large but may require tapping.
Elephantiasis
As the result of recurring attacks of lymphangitis the tissues of the affected part show the effects of lymphatic obstruction by an hypertrophy of the skin and subcutaneous tissues. It would seem that the combination of lymphatic obstruction and bacterial infection is necessary for the production of elephantiasis. The skin of a part affected with elephantiasis is rough and the hair scanty. In addition to the lymphoedema of the part there is a great increase in the connective tissue.
On account of the lymphatic stasis incision into the blubbery tissue causes the outpouring of much lymph.
Elephantiasis of the lower extremities is by far the most common situation, giving us probably 90% of such affections. In Fiji elephantiasis of the upper extremities is quite common.
Other favorite sites are the scrotum, vulva, breasts and penis. Rarely the scalp or areas about neck or trunk may show involvement.

Surgical treatment is the one usually followed. When an extremity becomes too much of a burden, amputation may be indicated. The employment of the method of lymphangioplasty, which consists in the introduction of silk threads into the subcutaneous tissues, to make a channel to the normal lymphatics, does not seem to have been attended with any degree of success or at any rate permanent results. These wounds tend to become infected and if this does not occur the new channels are speedily obliterated.
Castellani recommends the use of Merck’s fibrolysin in injections of from 2 to 4 cc. daily, for three to six months. After each injection the part is tightly bandaged with flannel or rubber bandages. The injections may either be made into the affected part or into the gluteal region. Massage prior to the bandaging may give better results. When the limb becomes smaller and the skin smoother, long strips of skin and subcutaneous tissue may be dissected out and the adjacent edges sutured.
In considering the advantages of operation in elephantiasis of the scrotum it is usually stated that the only question involved is the removal of a burdensome mass which in no way is a source of danger to the life of the patient. At the same time such patients are subject to attacks of elephantoid fever, a condition not without its dangers. There is one factor not usually brought forward and that is the remarkable effect of a successful operation on the mental state of the patient. This is well shown in the accompanying illustrations of the patient before and after[349] operation. If sexual deficiencies are of so powerful an influence on persons of education how much greater must they weigh on an uneducated native with but few of the higher interests of life.
Prior to operation the patient should be kept in bed for a day or so to lessen the amount of fluid and to secure relaxation of tissues. Thorough scrubbing with soap and water the day of and the day before the operation and the use of alcohol as an antiseptic are important. Some prefer iodine.

For the operation the lithotomy position is employed. An assistant supports the scrotal tumor wrapped in a sterile towel. Fauntleroy, whose method I give, does not recommend a tourniquet to the base of the tumor as in his opinion it assists but little in controlling haemorrhage and endangers asepsis. Haemostats answer better and as the vessels which give most trouble are deeply situated the elastic cord would not affect them. In some cases there is very little bleeding. The upper part of the[350] pear-shaped tumor usually affords sufficient sound skin next the thighs for the flaps. As a rule the elephantoid tissue does not involve the upper 2 or 3 inches of the skin anteriorly, which is thus available to cover in the base of the penis. In addition to this covering for the penis we have a long prepuce which has been considerably stretched so that after removing all elephantoid tissue there is enough sound prepuce remaining to cover the distal 2 or 3 inches, so that usually there is sufficient sound skin for a 5-inch penis.

The flaps which are to cover the penis and testicles should be mapped out with shallow incisions and care must be exercised that only sound skin is included in these flaps. A horseshoe shaped incision is made commencing at the left side of the base of the tumor about 1 inch from the thigh and about at the level of the penis in health. The incision is carried downward and passes just below the opening of the penis on[351] the tumor surface. A similar incision on the right side completes the horseshoe curve. Next a downward incision in the sound skin is made over the posterior surface of the tumor, thus encircling the base of the scrotum. The anterior horseshoe incision is now deepened to free the penis, care being taken not to injure the spermatic cord. Next the incisions are deepened laterally until the testicles are reached. The testicles are usually in the center of the tumor imbedded in a blubbery tissue from which they can be easily stripped. The remains of the gubernacula are then hooked up and cut close to the testicles. The tunicae vaginales are often thickened and contain fluid which has to be drawn off.
In 60% of Fauntleroy’s cases it was necessary to remove one testicle on account of extensive disease. One must also bear in mind the possibility of hernial complications and undescended testicle.
A sound is now introduced into the urethra and the septum of the scrotum divided close to the sheath of the penis, then dissecting away the blubbery tissue. At this stage there may be considerable bleeding.
The testicles and spermatic cords are then dissected away from the tunicae vaginales. The penis is now freed by a circular incision around and above the opening in the anterior part of the mass. The remainder of the horseshoe flap is now dissected up and the penis freed. The proximal covering for the penis is made from this horseshoe flap which is stitched to the distal one shaped from the prepuce, carefully trimmed of elephantoid tissue.
The lateral flaps are brought together with linen or silk-worm gut sutures leaving space for a drainage tube and we thus form a new scrotum for the testicles.
The mortality is usually given as 5% but Fauntleroy did not lose a case among 149 such operations, the tumors varying from 10 to 85 pounds in weight.
Chylous Hydrocele
Filarial affections of the tunica vaginalis or the testicle itself are not rare. In the milky fluid obtained by tapping such a hydrocele we may find filarial embryos.
Besides chylous hydrocele we may have a chylous ascites or a chylous diarrhoea. Where there is no obstruction to the thoracic duct there is less fat and the condition is more properly a lymphocele rather than a chylocele. The same distinction is applicable to the other conditions connected with lymphatic varices due to lymphatic obstructions other than that of the thoracic duct.
Laboratory Diagnosis
The blood from a needle prick of the finger tip or the lobe of the ear can be examined as a fresh preparation. It is advisable to make a vaseline ring around the drop of blood on the slide and then apply a cover-glass. Such a preparation will permit of the examination of the living embryos for a day or more.
Smear preparations may be made by the Ehrlich method of drawing cover glasses apart or by the Daniels method on slides. Some prefer making a thick smear of a drop of blood and, after it has dried, carefully to dehaemoglobinize it with water and then staining with dilute haemotoxylin. Staining with Leishman’s or Wright’s stain gives beautiful pictures. Fixation with methyl alcohol or with heat, by burning off a film of alcohol, and then staining with Giemsa’s stain or some haematoxylin preparation, is to be recommended. On the whole I consider haematoxylin the most desirable staining reagent, as such preparations hold their color for a long time. The paper-like sheaths are seen as if twisted about the larvae with their violet-stained cells. One should note a break in the violet-stained cell column which is 50µ from the head end of F. bancrofti and 40µ for L. loa.
A V spot is seen posterior to the break in the cell column and shows best with very light staining.
The break in the column of the cell nuclei marks the position of the nerve ring, which is distant from the head one-fifth the total length. The anterior spot, below the break in the cell column, is distant about 30% of the total length. It is the location of the excretory pore. In F. bancrofti the cell nuclei extend to 95% of length, thus differing from those of L. loa, which fill up the tail end. At about 82% of the length from the head is located the anal pore.
Ruge’s thick film method for malarial parasites gives excellent results in staining filarial embryos. Either the Giemsa or haemotoxylin staining may be employed.
Embryos may be found in the lymph from varicose groin glands or in the exudate from a chylous hydrocele, as well as in the urinary sediment from a case of chyluria.
The failure to find embryos in no way negatives the existence of a filarial infection.
Adult filariae, either alive or dead and calcified, may be found in the lymphatic glands or in the contents of filarial abscesses.
The blood shows an eosinophilia.
LOA LOA
This filarial infection is at present only known for the West Coast of Africa. In the Cameroons and in Old Calabar the infection is quite common.
As noted in the table previously given, the adults which are a little more than an inch long have cuticular protuberances or bosses, about 12 to 15 microns in height. The sheathed embryo is very similar to that of F. bancrofti, but has a more twisted tail and shows a complete filling up of the tail end with rather elongated cells. The lines of the curves of the embryo show irregularities and are not the smooth lines characteristic of F. bancrofti embryos.
The periodicity is diurnal, for which reason the parasite was originally termed F. diurna.
Leiper has reported two species of Chrysops, one of the tabanid biting flies, as transmitting agents and considers that the embryos undergo development in the salivary glands of the fly.
The life history is not well understood but as a rule a period of several years elapses after infection before adult filariae or filarial embryos are found. Again, for some reason, adult filariae may be noted and when extracted be found full of embryos and yet embryos not be found in the peripheral circulation.
The adults are noted for their tendency to move about in the subcutaneous connective tissues having been found in such tissues in the region of scalp, trunk, penis and extremities.
Most frequently, however, they are noted in the tissues about the region of the eyes and even under the conjunctivae, from which location they have been frequently extracted. It is this which has caused the name Filaria oculi to be given the worm.

The course of the wandering worm is usually marked by an oedematous track. In his own case, recently reported by a medical man, the first symptoms were transient painless swellings about the joints, associated with stiffness. Various diagnoses, such as rheumatism, erythema nodosum and angioneurotic oedema were made in his case. Although two adult filariae were removed at different times the blood examinations were negative for embryos.
As a rule the appearance of the worms in the subcutaneous tissues is characterized by itching sensations and a feeling of tension. Warmth causes them to appear in the superficial tissues while cold makes them confine themselves to the deeper structures. Eosinophilia is rather pronounced.
Calabar Swellings.—Although we have no absolute proof that these usually painless swellings, which occur rather suddenly on various parts of the body having only a thin layer of connective tissue, as forearms, face, ankles, hands, are connected with an infection with L. loa, yet such is the general view. These swellings are about the size of a hen’s egg, do not pit on pressure and last for about three days. There is marked tension over the swellings and they may itch greatly.

Fig. 104.—L. loa in the subcutaneous tissues, twice normal size. (From Greene, after Fülleborn.)
Rarely does one note more than one swelling at a time. Eosinophilia is quite marked during the attacks. Manson thinks the oedema results from the extrusion of embryos from the female at the site of the swelling. Ward considers the cause to be toxic material excreted by the worm.
There is very little of importance in connection with treatment. When the worms, which travel in the tissues about the eye, at the rate of about ½ inch per minute, are noted, some local anaesthetic may be used and the worm seized with forceps and extracted through a small incision. Elliot recommends the application of hot fomentations to the eye and upon the appearance of the worm under the conjunctiva to instill cocaine solution, seize the worm with forceps and then pass a silk ligature through the conjunctival fold taking in the worm. The ligature is tied and an incision made through which the worm is extracted. Cooling local applications, or an ichthyol ointment, may be applied to the Calabar swellings.
ONCHOCERCA VOLVULUS
This name is given to a filarial worm, found principally on the West Coast of Africa, which causes the formation of subcutaneous tumors. In certain localities as many as 10% of the population may be infected. More recently the parasite has been reported from Guatemala.
It is supposed that the adult worms cause an inflammation of the lymphatic vessel in which they may lie and that a formation of new connective tissue results, giving rise to a tumor-like mass, which is most often found in the axilla or about[355] the sides of the thorax. This tissue stroma encompasses the worms except for the anterior extremity of the female, with its uterine opening, and the posterior extremity of the male carrying the spicules, which ends lie loose in a sort of cyst-like dilatation, which is filled with a viscid fluid swarming with unsheathed embryos. These tumor-like masses cause very little discomfort, last indefinitely and do not tend to ulcerate.
It was formerly thought that these larvae were absent from the peripheral circulation but more recent investigations in cases of onchocerciasis have shown sheathless larvae in the blood, which had the characteristics of those in the contents of the tumors. Such findings, however, are of extreme rarity, the blood examination being almost invariably negative.
The cysts are usually found on the sides of the chest and are quite superficial, with the skin freely movable over them. They may be as large as a hen’s egg but usually are smaller. They are also found over trochanters or along the crests of the ilium.
Dubois states that the embryos may be found in juice from puncture of groin glands.
The tumors are easily enucleated.
In the American infections the tumours are more common in the regions near the eye and it has been thought that certain cases of keratitis may be due to onchocerciasis.
DRACUNCULUS MEDINENSIS
The disease caused by infection with this parasite is usually termed dracontiasis and the parasite Dracunculus medinensis or the Guinea worm.
The geographical distribution includes India, Arabia, the West Coast of Africa and Brazil.
Life History.—The male has not surely been seen in man so that the pathological condition is entirely connected with the female worm. Almost invariably the female worm, which measures about two feet long by 1/12 inch broad, tends to wander down to the connective tissue structures of the lower extremity. In about 10% of the cases the worm may present elsewhere, as scrotum, back or arms. At the posterior extremity there is a sort of anchoring hook.
With the anterior extremity the worm presses against the overlying skin and causes the formation of a blister-like lesion.
This vesicle later on bursts and, if water is applied to the spot, a delicate tube, the uterus, is extruded and there exude a few drops of a milky fluid, which swarms with the sharp-tailed, striated, sheathless embryos. It is thought that the pouring forth of embryos, when water touches the part, is in order that the embryos may reach the water of a pool through which the infected native may be wading. Once[356] in the water of such a pool, the larvae are swallowed by Cyclops and gaining the body cavity of this little crustacean, they continue to develop for about one month.
During this period there are two ecdyses, the first after about two weeks, when the tail becomes blunt.
When one takes these infected cyclops into the stomach, by drinking water containing them, the cyclops is killed by the gastric juice and the Guinea worm larva breaks out of the dead intermediary host and bores its way through the stomach wall and possibly goes to the tissues about the retroperitoneal region. As a matter of fact we are in ignorance of the exact cycle which goes on, until the fertilized female, with her embryo-distended uterine tube, reaches the lower extremity. A cross section of the female shows the body of the worm to be almost entirely made up of uterus, with an insignificant alimentary canal pressed to one side.
The period of incubation is from 8 to 12 months.
Usually there are no other symptoms than discomfort from the blister and a feeling of heaviness about the affected extremity. At times there may be pain and fever. The parasite may fail to gain exit to the skin surface or die before reaching maturity. In such cases she may become calcified or give rise to abscess formation. The x-ray plate may show a convoluted cord-like structure with frequent breaks in the line.

Treatment.—By douching the point of exit we may cause the uterus to empty itself in about three weeks. At that time we may commence extraction by intermittent traction by winding the worm around a large toothpick or similar object. If undue force is exerted the worm may break off and abscess formation or sloughing result.
Macfie has reported success in treating 23 cases of dracontiasis with tartar emetic. He gave 1 grain intravenously every other day and found that it was not necessary to give more than 6 grains in the course of treatment. The inflammation quickly yielded and the discharge from the sore ceased rapidly.
CHAPTER XXIII
THE SCHISTOSOMIASES
General Considerations
There is a group of diseases, caused by trematodes of the family Schistosomidae, to which we apply the name schistosomiasis. The Schistosomidae differ from other human flukes (Trematoda) by not being hermaphroditic and by having nonoperculated eggs. From these eggs a ciliated embryo (miracidium) emerges which gains entrance to certain species of molluscs. In this intermediate host the miracidium gives rise to a sporocyst, which latter forms daughter sporocysts. These emerge from the mother cyst and enter the digestive gland of the mollusc and produce cercariae.
These cercariae show an absence of a pharynx and upon the rupturing of the sporocyst are discharged from the mollusc and furnish the infecting stage for penetrating the skin of man or other animal.
There are those who think the entrance is effected through mucous membranes, especially those of the mouth, genitalia and anus and even the nasal mucosa.
It is generally admitted that infection by drinking water, containing the ciliated embryos, is impossible, owing to the rapidity of their destruction by solutions of HCl of similar strength to that of the gastric juice.
Infecting mice with S. japonicum cercariae from snails mashed on the abdominal surface of the mouse, it was found by Suyeyasu that after penetrating the skin the cercariae went to the right heart by way of venous and lymphatic channels. From the pulmonary vessels they penetrate the lungs and go by way of the mediastinum or pleura to the diaphragm which they penetrate and make their way to the abdominal cavity next penetrating the liver and entering the portal vein.
It is probable that the earlier stages of development take place in the portal vein and that having reached maturity the female attaches herself to the male and together they go, by way of the inferior mesenteric vein, to the haemorrhoidal or vesical terminals. The male is in the shape of a narrow leaf, about ½ inch long with a ventrally turned oral sucker and a closely adjacent ventral sucker. The[358] female is a somewhat longer and cylindrical worm almost an inch in length and, like the male, has two suckers. There is a dark brown zig-zag stripe which shows prominently in the posterior part of the female and outlines the blood-filled intestinal tract. When the female applies herself to the ventral surface of the male there is an infolding of the sides of the flattened surface giving the male a cylindrical outline and resulting in the formation of a canal containing the female (gynaecophoric canal).

Fig. 106.—Schistosoma japonicum (male and female). The sharp edges of the borders at the beginning of the gynaecophoric canal formed by the male are an accidental appearance. (From Mense.)
The males of the flukes which cause the vesical (Schistosoma haematobium) and the rectal (Schistosoma mansoni) involvement are covered externally with small tubercles and have a ventral sucker only slightly[359] larger than the oral one. The Japanese schistosome (Schistosoma japonicum) is slightly smaller, has a smooth surface and shows a prominent pedunculated ventral sucker of much larger size than the oral one.
Both suckers are larger than those of the other species.
The eggs of S. haematobium have a terminal spine and measure from 115 to 175 by 60 microns; those of S. mansoni have a lateral spine and measure from 110 to 125 by 50 microns while those of S. japonicum are devoid of spinous projections and measure about 100 by 70 microns.
Clinically, the three infections differ as will be noted further on.
Looss claims that the two tuberculated species are identical and that the lateral spined egg is the product of an unfertilized female. He has more recently regarded the egg as produced parthenogenetically. Other helminthologists have noted slight anatomical differences as to ovaries and testicles so that the consensus of opinion is that vesical and rectal bilharziases are caused by different species of the genus Schistosoma.

Recently Leiper has found cercariae showing the absence of a pharynx (characteristic of the genus) in a Japanese mollusc. Such molluscs were teased out in water and laboratory bred mice immersed therein. One of these mice was killed a month later and adult schistosomes were found in the portal vessels. Leiper has also found cercariae showing absence of pharynx in four different species of molluscs in[360] Egypt. With such molluscs he was able to infect white rats and other animals. He states that infection with these cercariae from the mollusc host can bring about infection either by way of the mouth or through the skin. Sodium bisulphate in a strength of 1 to 1000 killed these cercariae almost immediately.
It would therefore seem proven that all human schistosome infections take place following cercarial and not miracidial development. As proof that S. haematobium and S. mansoni are different species, Leiper notes that mice infected by molluscs of the genus Bullinus showed schistosomes with terminal spined eggs, the ovary lying in the lower half of the female. The male had four or five large testes. In mice infected by molluscs of the genus Planorbis, the eggs were lateral spined, the ovary was in the anterior half of the body and the male had eight small testicles.
The mollusc host of S. japonicum is Blanfordia nosophora. The shell of this snail is of cornucopia shape.
As these flukes are found in the blood vessels they are often referred to as the blood flukes.
History
Vesical schistosomiasis has undoubtedly existed in Egypt since ancient periods as vesical calculi are frequent in the mummies of various dynasties. Ruffer has found calcified schistosome ova in the kidney of a mummy.
The French troops suffered greatly from the disease in 1800. It was Bilharz in Cairo, in 1851, who first associated the haematuria with the presence of the parasite and it is from his name that we get the designation bilharziasis or bilharziosis for the disease.
In 1903, Manson found lateral spined eggs in a patient from the West Indies who was suffering from rectal rather than bladder symptoms. In 1907 Sambon, considering the points of difference between the eggs and the involvement of rectum rather than bladder, established a new species, S. mansoni.
In the West Indies, as shown by the reports of Surgeon Holcomb from Porto Rico, rectal bilharziasis is rather common.
For a number of years Japanese physicians had noted the existence of a disease characterized by splenic and hepatic enlargement, ascites and cachexia. In August, 1904, Katsurada discovered ova with a ciliated embryo in the stools of patients with this disease. He found schistosomes in the portal vessels of dogs and cats containing eggs similar to those seen in the human cases. He named this trematode S. japonicum. In November, 1904, Catto discovered the parasite at an autopsy on a Chinaman. In 1910 Lambert, in China, described a disease, which he called urticarial fever, and a short time afterward Houghton established the connection between this disease and the more advanced stages of Japanese schistosomiasis.


Pathology
The pathological lesions are almost entirely due to the irritation of the eggs with resulting connective tissue increase or ulcerative processes. For some reason these flukes select the inferior mesenteric vein and make their way to the vesical plexus of veins in the case of S. haematobium and to the haemorrhoidal vessels for the other species. At times the ova or worms may be carried over to the systemic veins by way of the channels of anastomosis. In the terminal vessels the female gives off the eggs which penetrate the adjacent mucosa giving rise to inflammatory thickenings and the extrusion of the irritating eggs into the lumen of the bladder or rectum.
In the bladder these terminal spined eggs cause haematuria and form the nucleus for vesical calculi. The mucosa may also show wart-like excrescences. If the eggs are swept back through the portal vessels to the liver an interlobular cirrhosis results which would seem to be due entirely to the irritation of these egg emboli and not to toxic products of the worms themselves. Marked ureteral and kidney lesions may result as complications of cystitis or primarily from irritation by ova. In women the vagina, vulva and cervix uteri may show papillomatous thickenings. Bilharzial lesions of the male urethra are not uncommon and may lead to fibroid thickenings and fistula.
In searching for the flukes at autopsy we should make a longitudinal slit in the portal vein and with a spoon scoop out the blood and search for the parasites in a glass dish.
In the intestinal form of schistosomiasis the rectum may be studded with polypoid tumors which when projecting from the anus may ulcerate and lead to a diagnosis of cancer of the rectum. In sections from these masses great numbers of lateral spined eggs may be found.
The connective tissue increase is in the submucosa. The gut section may also present small abscess-like areas.
Eggs have been found in the appendix as well as in the large intestines and the small intestine has been found involved in one case. In rare instances ova have been found in the lungs, spleen and even in the brain and spinal cord.
By digesting selected tissues in 4% NaOH at 75°C. and centrifuging one may find eggs which otherwise would be overlooked. Statistics from Cairo usually note 30 to 40% of infection in natives but Ferguson employing all methods found 61% infected at autopsies on 600 males. In all forms of schistosomiasis but particularly in the Japanese infection, eosinophilia is pronounced.
In Japanese schistosomiasis the intestines may show thickenings at the site of aggregations of eggs. In the liver a marked interlobular cirrhosis occurs with numerous eggs in the connective tissue increase.[363] Rarely, eggs may lodge in the brain, giving granuloma-like areas. The irritating eggs may also give rise to similar areas in the lungs.
Symptomatology
Vesical Schistosomiasis or Endemic Haematuria
This form of the disease is chiefly found in Egypt, Syria, Uganda and South Africa. It is caused by S. haematobium and the period of incubation is approximately six months.

The first symptoms are pricking sensations about urethra and slight haematuria which comes on at the end of the act of micturition. Excesses or fatigue are apt to increase the haematuria. The diagnosis is made by finding the ova in the sediment of the centrifuged urine.
Symptoms of cystitis and even pyelitis may follow the early bladder and urethral manifestations. Pain in the back or symptoms suggesting renal colic may be present. Anaemia and physical weakness gradually develop. An important sequel is vesical calculus. It is a question whether the eggs or some other product of the infection form the nucleus of such a stone. Not only can stone be recognized[364] by cystoscopy but rather distinctive are small, glazed yellowish nodules with areas of granulation tissue. Papillomatous growths may also be seen upon cystoscopy.
Perineal fistulae in the male and vaginitis in the female may be noted.
When reinfection does not occur the haematuria tends slowly to disappear but recovery does not usually take place for several years. The vesical schistosome (S. haematobium) often causes pathological changes in the rectum so that a case may show both vesical and rectal symptoms. The rectal schistosome (S. mansoni) does not give rise to vesical trouble.
Rectal Schistosomiasis
While terminal spined eggs may be found in rectal lesions, but usually combined with lateral spined eggs, in countries where the vesical form of the disease exists, yet there are many parts of the world where, with the exclusive existence of an intestinal bilharziasis, only lateral spined eggs are found. The infection resulting from S. mansoni is the sole one in the West Indies, Congo Free State and in North-eastern South America.
The symptoms are usually those of a chronic dysentery with more or less tenesmus and straining. Prolapse is a common result and is the cause of the ulcerations which may cause the disease to be diagnosed as cancer. Cirrhosis of the liver is more apt to occur than in pure vesical schistosomiasis.
Most writers fail to mention other than the later manifestations of rectal bilharziasis, the earlier symptoms being overlooked or attributed to other causes. The same was true of Japanese schistosomiasis in which the initial “urticarial fever” was only recognized as connected with the late manifestations of liver cirrhosis and ascites a few years ago.
In 1916 Lawton noted in a number of Australian soldiers, encamped in Egypt, a fever of about 7 to 10 days’ duration in which the evening rise approximated 103°F. A diarrhoea and abdominal pain accompanied the fever and along with this a cough and patchy consolidation. Most of the cases showed urticaria which lasted from one to seven days. All cases showed a well marked eosinophilia. The diagnosis, but frequently only after prolonged and continued search, was made by the finding of the lateral spined eggs of S. mansoni. The period of incubation in these cases seemed to be from one to three months.
Japanese Schistosomiasis
This is also called Katayama disease and in its early stages urticarial fever or Yangtse fever. It is caused by the nontuberculated species, S. japonicum, which is characterized by the egg without a spine.
Laning, in a study of 7 well-controlled cases, has shown that the disease sets in after two or three days from the time of exposure to infection, by wading through[365] paddy fields or still waters of infected ponds or lakes. The disease occurs in China, Japan and possibly in the Philippine Islands.

Fig. 111.—A and B, Case of Schistosoma japonicum. Severe infection of three years’ duration. Ova very abundant in stools. Liver dullness diminished. Spleen not enlarged. (From Jefferys and Maxwell.)
The course of the disease may be divided into 3 stages: the 1st, that of urticarial, pulmonary and febrile manifestations, which lasts about a[366] month; the 2d, where ova begin to show in the small mass of bloody mucus which may cap the stool, and finally the 3d stage with cirrhosis of the liver, ascites, cachexia and death.
In the 1st stage we have headache and an evening rise of temperature to about 101°F. or 102°F. Shortly after the onset urticarial lesions, which may be 2 or 3 inches in diameter, may appear and disappear on various parts of the body.
The pulse rate is usually low. Very characteristic and early manifestations are those of the pulmonary involvement. Here oedematous patches may give the signs of crepitation and consolidation to rapidly disappear and reappear in another part of the lungs.
These pulmonary manifestations and the associated fever frequently cause a diagnosis of broncho-pneumonia to be made. A dry hacking cough appears early and with the fever, etc., may make one think of tuberculosis. The urticarial lesions often cause a diagnosis of ptomaine poisoning to be made. The blood examination shows a marked eosinophilia, of from 30 to 60%.
The 2d stage shows more or less intestinal disturbance with at times bloody mucus containing ova. The ova may not be present for long intervals or may never be found. Where reinfection does not take place the patient tends to recover but if exposure to infection be kept up then the 3d stage sets in with rather marked dysenteric manifestations, emaciation, anaemia, ascites, dropsy and a terminal cachexia.
The bladder never seems to be involved in Japanese schistosomiasis. The eggs, however may be carried to the brain and produce symptoms of Jacksonian epilepsy.
Laboratory Diagnosis
This consists in the search for ova in the centrifuged urine of vesical bilharziasis or in the bloody mucus of the intestinal manifestations of the disease. If one adds water to the urine the ciliated embryo will be noticed to break out of the shell in a few minutes and move about actively as if in search for some host.
The eosinophilia is of great diagnostic value and is usually associated with an increase in the leucocyte count.
Fairley has introduced a complement fixation reaction in diagnosis, using an extract of the livers of infected snails as antigen. The reaction appears early in the infection but disappears in the later stages. It is a group reaction as the livers of Bullinus answer for the S. mansoni serum as well as for the specific S. haematobium serum.
Prophylaxis
Bathing should be allowed only in filtered water, there being an absence of the infecting cercariae in such a supply.
Then, too, if a water which does not contain fresh water snails is stored for three or four days the cercariae which might have been present in the freshly pumped up water will have died out, such free cercariae only surviving for about this period. The gastric juice will destroy cercariae so that it would seem impossible for an infection to occur by the alimentary tract atrium with the exception that cercariae might bore their way through the buccal mucosa as well as through the skin. The sterilization of the urine of cases of vesical bilharziasis and of the faeces in other forms should be carried out where practicable. It is now considered practicable to eradicate carriers of the infection with antimony treatment.
Treatment
The most important matter is to avoid places where the infection is known to exist. If one must wade through infected waters the body should be protected by canvas or other closely woven garments.
Of various treatments, having in view the destruction of the worm, such as salvarsan, etc., none seem to have been of any value except antimony.
Robertson has reported relief of symptoms from the administration of 2 grains of thymol dissolved in half a drachm of benzine. The treatment is continued for a few weeks. Others have not had good results from this treatment. Local treatment is necessary in treating the cystitis and prolapse of rectum. Operative procedures are indicated where calculi exist.
The results obtained by treatment with tartrate of antimony during the past three years justify us in considering bilharziasis as a disease which has a specific for its cure. Almost all cases will yield to a course of intravenous injections of from one-half to two grains of the drug, commencing with the smaller dose. The drug should be well diluted (25 to 50 cc. sterile saline). Some use a 1% solution but the higher dilutions are safer from a standpoint of avoiding phlebitis. Intravenous injections are made twice weekly and the total amount of drug given during the course should rarely exceed 25 to 30 grains. For details see under treatment of leishmaniasis.
CHAPTER XXIV
MINOR HELMINTHIC INFECTIONS
Paragonimiasis
General Considerations
This is an infection with a trematode, Paragonimus westermanni (P. ringeri) (Distoma pulmonale). It is rather common in some parts of Japan and Formosa.

Fig. 112.—Paragonimus westermanni: natural size; to left showing ventral surface; to right showing dorsal surface. (Braun after Katsuruda.) (From Tyson.)
Arce has recently reported cases of paragonomiasis in three Peruvians who had been in contact with Japanese immigrants.
In 1880, Baelz found the ova in the sputum of a case of haemoptysis in a Japanese, as did also Manson in a Chinaman. Manson’s case subsequently died and when autopsied showed in his lungs a fluke which was responsible for the eggs seen by Manson. The fluke itself is a little more than ⅓ of an inch (8 mm.) long and is almost round on transverse section, there being, however, some flattening of the ventral surface. The acetabulum is conspicuous and opens just anterior to the middle of the ventral surface.
The branched testicles are posterior to the laterally placed uterus and the genital pore opens below the acetabulum. The branched ovary is opposite the uterus on the other side.
It is rather flesh-like in appearance and is covered with scale-like spines. The flukes are usually found in tunnels in the lungs, the walls of which are thickened connective tissue. These tunnels result from hypertrophy of the bronchioles. There may be also cysts formed from the breaking down of adjacent tunnel walls. In addition to lung infection with this fluke, brain, liver and intestinal infections may be found.
The life history and mode of infection of man, further than the miracidium stage, has been unknown until recently. If the eggs in the sputum are shaken up with water and the water renewed from time to time a ciliated embryo or miracidium develops after a few weeks and, at this time if one presses on a cover-glass covering some of these more mature ova, the miracidium will break through the operculated extremity of the egg and swim about actively in the surrounding water.

Nakagawa has found that the miracidia infest certain fresh water molluscs and become cercariae in this first intermediate host. From this host the cercariae go to certain fresh water crabs and encyst in this second intermediate host, either in the liver or in the gills. In Japan one of these crab hosts, Potamon dehaanii, is eaten both raw and cooked.

Fig. 114.—Paragonimus westermanni; photograph from a sexually immature specimen. (From Tyson.)
Experimental feeding of puppies on infected crabs brought about infection with the lung fluke. It is thought that the fluke, after leaving the cyst, goes through the intestine to the abdominal cavity. Thence it perforates the diaphragm and enters the pleural cavity, finally penetrating the lung to become encysted there. The lung is the favorite site but wandering flukes may invade other tissues and organs even invading the central nervous system.
Besides man, dogs, cats and especially hogs may be infected.
Symptomatology, Diagnosis and Treatment
The case is usually considered as one of chronic bronchitis on account of the occurrence of cough and morning expectoration of a gelatinous sputum which is usually brownish. It is popularly known[370] as endemic haemoptysis for the reason that after violent exertion, or at times without manifest reason, attacks of haemoptysis of varying degrees of severity come on. The signs on percussion are usually insignificant while those on auscultation at the time of haemoptysis are often marked. The symptoms often disappear for months to again reappear.

Fig. 115.—Anatomy of trematoda (flukes) of man. O S, oesophageal sucker. Ph, pharynx. Oes, oesophagus. O P, genital pore. V S, ventral suckers or acetabulum. Ut, uterus. Int, intestines. Ov, ovary. Sh G, shell gland. T, testicles. T G, yolk glands or vitellaria. Exc, excretory pore.
The course of the disease is very chronic, often lasting many years. As a rule the patient is fairly well nourished although recurring attacks of haemoptysis may[371] bring on a rather marked anaemia. Jacksonian epilepsy has been reported as occurring in paragonomiasis, the ova being found in cysts of the brain. There is some question as to whether some of the reports as to paragonomiasis may not have been connected with infections with Japanese schistosomiasis.
The diagnosis of endemic haemoptysis is readily made by finding the operculated eggs in the more or less sanguinolent sputum. These eggs are of a light yellow color and average 90 × 65 microns. One often sees Charcot-Leyden crystals in the sputum.
As prophylactic measures we should forbid uncooked crabs or crayfish. The sputum should be sterilized.
The treatment is entirely symptomatic.

Clonorchiosis
This is an infection due to a trematode, Clonorchis endemicus (Opisthorchis sinensis). It is also referred to as human liver fluke disease. It is true that the common liver fluke of sheep, Fasciola hepatica, may occur in man but such infections are rare, only 23 cases having been reported. Another liver fluke of ruminants is the lancet fluke, Dicrocoelium lanceatum, but it is also unimportant for man, only 7 cases having been reported.
Clonorchis infections are common in China and Japan, the fluke being about ½ inch long by ⅛ inch wide. There is considerable dispute as to whether we have a pathogenic and nonpathogenic Clonorchis; the name C. endemicus applying to the former and C. sinensis to the latter.
Looss considered the nonpathogenic C. sinensis to be larger (13-19 mm.), to show pigment in its parenchyma and to have breaks in the vitelline glands. C. endemicus was reported as smaller (10 to 13 mm.), and without pigment or breaks in the continuity of the vitellaria.
The eggs of this fluke show slightly concave bending of the sides at the operculated end and are about 30 × 16 microns. These flukes are found within the thickened bile ducts and may be present in great numbers. They may invade the pancreas as well as the liver.
These flukes are found in dogs and cats as well as man.
This fluke is supposed to produce most serious symptoms as indigestion, swelling and tenderness of liver, bloody diarrhoea, ascites, oedema and a fatal cachexia.
The course of the disease is insidious and chronic with periodic improvement.
As a matter of fact, many physicians in China attribute very little pathogenic importance to it. The disease is diagnosed by the presence of the ova in the stools. The source of infection is probably through the eating of uncooked fish.

Kobayashi has examined various molluscs and fish for trematode larvae. He succeeded in infecting nine kittens and two cats by feeding them with certain fresh water fishes whose flesh contained trematode larvae. These fishes were found in districts where human distomiasis was common.
Further experiments by Kobayashi have shown that the larval flukes leave the cyst and start for the biliary passages. When the flukes are very numerous the size is smaller. Maturity is reached in four weeks. This investigator believes that the primary intermediate host is a mollusc as cercariae found in these hosts are very similar to the larval forms found in fish.
He does not consider that there are two species concerned in Clonorchis infections, as he has found variations in continuity of vitellaria in small as well as large flukes. Number of parasites present influences size. Age influences pigment production.
Another human fluke, Opisthorchis felineus, inhabits the gall bladder and bile ducts of man and it is stated that the infection is quite common in Siberia.
It is also a parasite of cats and dogs.
Both Clonorchis and Opisthorchis have the testicles in the posterior end with the uterus anterior. The testicles of Clonorchis are branched (dendritic) while those of Opisthorchis show as two lobes. In Dicrocoelium the lobed testicles are anterior to the uterus, which fills up the posterior end of the fluke.
The mode of infection as well as the life history is not known but is probably connected with the eating of raw fish.
The symptoms are similar to those caused by C. endemicus.
The fluke has two-lobed testicles as against the dendritic one of C. endemicus.
Intestinal Distomiasis
The most important intestinal fluke is undoubtedly Fasciolopsis buski. It is now thought that this infection is more common than was previously stated. Goddard states that more than 5% of stools examined in Shaohing, China, show eggs of this parasite. It is a very large fluke with an acetabulum 4 times the diameter of the oral sucker. It is characterized by a very long and prominent cirrus.
F. buski and Fasciola hepatica are much alike in size and outline. The acetabulum of the latter is only 1.6 times the diameter of the oral sucker and the alimentary tract shows branching which is best seen in the cone-shaped projection of its anterior extremity. F. hepatica is a liver fluke rarely found in man.
F. buski is found in China, Assam and India. It is a parasite of hogs as well as man. The eggs measure from 80 to 120 microns, are nearly colorless and have a thin shell with a very small operculum.
The symptoms are chiefly those of a chronic diarrhoea followed by anaemia and wasting. The stool is light yellow in color, exceedingly offensive and does not contain blood. Goddard thinks that they live in the upper part of the small intestines.
The life history is unknown but Goddard states that fresh water snails are much eaten by the people of Shaohing. Nakagawa notes that the eggs of Fasciolopsis hatch in two to three weeks. The miracidia penetrate various species of snails in which the cercariae may encyst and infect pigs eating such snails. The cercariae may also leave the snail and encyst on blades of grass, to later infect an animal feeding on the grass, this latter method of infection resembling that of Fasciola hepatica.
Noc has reported success with treatment with thymol and Goddard with beta-naphthol.
Other intestinal flukes such as Cladorchis watsoni, Gastrodiscus hominis, Heterophyes heterophyes, and Fascioletta ilocana are of less importance. Heterophyes is[374] probably a rather common parasite but owing to its very small size (2 mm.) has been generally overlooked at autopsy.
Strongyloides Stercoralis
It was formerly supposed that a chronic form of diarrhoea in Cochin China was due to an infection with the parthenogenetic female of Strongyloides stercoralis. It is now known that the parasite is widely distributed over the tropical and subtropical world and that it rarely gives rise to manifest symptoms although some observers regard it as capable of producing diarrhoea and more or less anaemia.


It seems to be capable of setting up quite an eosinophilia at the time the adult female is penetrating the crypts of Lieberkühn, so that it is probably of pathogenic importance.

Fig. 120.—A, Egg of Strongyloides intestinalis (parasitic mother worm) found in stools of case of chronic diarrhoea; B, Rhabditiform larva of Strongyloides intestinalis from the stools. (William Sydney Thayer, in Journal of Experimental Medicine.)
The parasitic or intestinal form (also known as Anguillula intestinalis) is represented only by females. These are about 1/12 of an inch (2 mm.) long and reproduce parthenogenetically. They have a pointed, four-lipped mouth, and a filariform oesophagus which extends along the anterior fourth of the body. The uterus contains a row of 8 to 10 elliptical eggs which stand out prominently in the posterior part of the body by reason of being almost as wide as the parent worm.
They usually live deep in the mucosa and the embryos emerge from the ova laid in the mucosa. The embryos escape from the eggs while still in the intestines, so that in the faeces we only find actively motile embryos. The eggs, which are strung out in a chain, never appear in the faeces except during purgation. As they greatly resemble hookworm eggs this is a point of great practical importance.
In fresh faeces we find hookworm eggs and Strongyloides embryos. The embryos are rather common in stools in the tropics. These embryos have pointed tails and are about 250 × 13 microns. They have a double oesophageal bulb. They are about 250 microns when they first emerge but may grow until they approximate 500 microns in the faeces. The mouth cavity of the embryo of the hookworm is about as deep as the diameter of the embryo at the posterior end of the mouth cavity; that of Strongyloides is only about one-half as deep as the diameter. If the temperature[376] is low, below 15°C., these rhabditiform embryos develop into filariform embryos, which form the infecting stage.
It has been demonstrated by Fülleborn that infection of man takes place through the skin. If the temperature is warm, 25° to 35°C., these embryos develop into the free-living form. In this we have males and females, with double oesophageal bulbs, the male about 1/30 of an inch (¾ mm.) long with an incurved tail and 2 spicules and the female about 1/25 inch (1 mm.) long with an attenuated tail. These copulate and we have produced rhabditiform larvae, which later change to filariform ones. At this time the length is about 550 microns. These start up the parasitical generation.
For treatment thymol is usually recommended. Stiles speaks highly of sulphur.
CHAPTER XXV
TABLE OF IMPORTANT ANIMAL PARASITE DISEASES
Protozoal Diseases
| Parasite | Defin. host | Intermediate host | Important reservoir of virus | Transmission and pathogenicity |
| Entamoeba histolytica. | Man. | Not required. | Man-carrier stage (feces). | Cysts in food or water. Flies may act as carriers. Ingestive. Amoebic dysentery. |
| Balantidium coli. | Man (hogs). | Not required. | Man-carrier stage (hogs). | Transmission probably same as for E. histolytica. Found in those having care of hogs. Ingestive. Balantidium dysentery. Anaemia. |
| Lamblia (Giardia) intestinalis. | Man (mice and rats). | Not required. | Man-carrier stage (mice and rats). | Transmission probably same as for E. histolytica. Rat feces on human food important. Ingestive. Lamblia dysentery. Giardiasis. |
| Spiroschaudinnia (Spironema) recurrentis, carteri, etc. (louse group.) | Louse (P. vestimenti). | Man.(*) | Man (blood). | Cyclical development in louse. Bite puncture contaminated by crushed louse. Relapsing fever. |
| Spiroschaudinnia (Spironema) duttoni, novyi. (Tick group.) | Tick (species of Ornithdorus or Argas). | Man.(*) | Man (blood). | Excretions of tick contaminating tick-bite. Tick fevers. Relapsing fever. |
| Treponema (pallidum and pertenue). | Man. | Not required. | Man. | T. pallidum. Usually venereal. Syphilis. T. pertenue. Flies or contact. Yaws. |
| Leptospira icterohaemorrhagiae. | Man (rat). | Not required. | Rat. | Common infection of rats. Present in blood. Excreted in urine. Ingestion. Weil’s disease. |
| Leptospira icteroides. | Mosquito (Stegomyia calopus) | Man. | Man (blood). | Cyclical development in mosquito—12 days. Inoculative. Yellow fever. |
Protozoal Diseases (Continued)
| Parasite | Defin. host | Intermediate host | Important reservoir of virus | Transmission and pathogenicity |
| Leptospira morsus-muris. | Man (rat). | Not required. | Rat. | Man inoculated by bite of infected rat. Rat bite fever. |
| Trypanosoma gambiense and rhodesiense. | Fly (Glossina species) | Man. | Man—game animals? (blood). | Cyclical development in tsetse fly. Inoculative. Sleeping sickness. |
| Schizotrypanum cruzi. | Lamus megistus | Man. | Man. | Cyclical development in bug. Inoculative. Brazilian trypanosomiasis. |
| Leishmania (donovani, infantum, and tropica). | Not surely known. | Man. | Man. | L. donovani—Bed bug? kala-azar. L. infantum—dog flea? infantile leishmaniasis. L. tropicum—biting insects? Oriental sore; American leishmaniasis. |
| Plasmodium malariae, vivax and falciparum. | Mosquito (Anopheline species) | Man (with schizonts). | Man (blood) (with gametes). | Cyclical development in mosquito—12 days. Inoculative. Malaria. |
| Rickettsia prowazeki. | Man. | Louse (P. vestimenti). | Man (blood) | Cyclical development in louse. Bite puncture inoculated by louse feces. Typhus fever. |
| Dermacentroxenus rickettsi. | Man (goats, rodents, etc.). | Tick (Dermacentor andersoni). D. venustus. | Goats and rodents. | Excretions of tick contaminating tick-bite. Rocky Mountain fever. |
| Bartonella bacilliformis. | Man. | Unknown. | Man (blood) | Transmission unknown. Species of Phlebotomus suggested. Oroya fever. |
Note.—(*) Some authorities give man as definitive host of Spiroschaudinnia (Spironema). Diseases often classified as filterable virus ones of protozoal affinity are (1) Dengue. Cause unknown. Transmitted by Stegomyia species. (2) Pappataci fever. Cause unknown. Transmitted by Phlebotomus species. Other protozoal diseases are (1) Tsutsugamushi. Probably a protozoan. Transmitted by Kedani mite. (2) Trench fever. Probably Rickettsia. Transmitted by louse.
Helminthic Diseases—Trematodes
| Parasite | Defin. host | Intermediate host | Important reservoir of virus | Transmission and pathogenicity |
| Clonorchis sinensis. | Man (cats, dogs and hogs). | 1st, snail (Melania libertina)? and 2d, fish | Man. | Not definitely known. Eating raw fish. Ingestive. Human liver fluke disease. |
| Opisthorchis felineus. | Man (cats and dogs). | 1st, mollusc. 2d, fish. | Cats and dogs. | Man infected by eating raw fish. Ingestive. Liver fluke disease. |
| Fasciolopsis buski. | Man (pig). | Possibly 1st, mollusc. Cercariae encyst on grass. | Hog. | Not definitely known. Intestinal Distomiasis. |
| Heterophyes heterophyes. | Man (dogs and cats). | 1st, probably mollusc. 2d, probably fish. | Dogs and cats. | Not definitely known. Intestinal Distomiasis. |
| Paragonimus ringeri. | Man (dogs, cats and hogs). | 1st, snail. 2d, crab. | Cats, dogs and hogs. | Eating raw crabs containing cercariae. Ingestive. Lung fluke disease. |
| Schistosoma haematobium. | Man. | Snail (Bullinus). | Man (urine). | Bathing or drinking water containing cercariae. Penetrative. Vesical bilharziasis. |
| Schistosoma mansoni. | Man. | Snail (Planorbis). | Man (feces). | Bathing or drinking water containing cercariae. Penetrative. Rectal bilharziasis. |
| Schistosoma japonicum. | Man. | Snail (Blanifordia). | Man (feces) domesticated animals). | Bathing or drinking water containing cercariae. Penetrative. Katayama disease. |
Note.—Rare trematodes of man are (1) Fasciola hepatica. Chiefly disease of sheep. Cercariae from snail (Limnea) encyst on grass. (2) Dicrocoelium lanceatum. Chiefly disease of cattle. (3) Heterophyes nocens. A very small intestinal fluke of man. (4) Metagonimus yokogawai. Another very small intestinal fluke of man. Intermediate hosts: mollusc and gold fish. (5) Echinostoma ilocanum. A rare intestinal fluke of the Philippines. (6) Two genera of Paramphistomidae—Cladorchis and Gastrodiscus. Intestinal flukes.
Helminthic Diseases (Continued). Nematodes
| Parasite | Defin. host | Intermediate host | Important reservoir of virus | Transmission and pathogenicity |
| Filaria bancrofti. | Man. | Mosquito (various species). | Man infected (blood). | Indirect in mosquito. Mature larva penetrates skin. Elephantiasis, etc. |
| Loa loa (F. loa). | Man. | Fly. Species of Chrysops (mangrove flies). | Man infected (blood). | Probably indirect (cyclical) in Chrysops. Probably inoculative. Ocular filariasis, etc. |
| Acanthocheilonema perstans (F. perstans). | Man. | Not definitely known. | Man infected (blood). | Transmission by mosquitoes and ticks suggested. No pathogenicity. |
| Dracunculus medinensis. | Man. | Species of cyclops. | Man infected (subcutaneous tissue). | Larvae enter cyclops. Infected cyclops in drinking water. Ingestive. Guinea worm infection. |
| Onchocerca volvulus (F. volvulus). | Man. | Not definitely known. | Man (blood?). | Possibly Glossina. Subcutaneous tumor and lymphangitis. |
| Strongyloides stercoralis. | Man. | Not required. | Man (feces). | Parasitic filariform larva penetrates skin. Pathogenicity doubtful. |
| Necator americanus and Ancylostoma duodenale. | Man. | Not required. | Man (feces). | Encysted strongyloid larvae penetrate skin. Ancylostomiasis. |
| Trichinella spiralis. | Man (rat and hog). | Hog (man and rat). | Hog (muscle). | Encysted larva in raw or insufficiently cooked pork. Ingestive. Trichinosis. |
Note.—Ascaris, Trichuris and Oxyuris do not require intermediate host. With Ascaris and Trichuris, larva gradually develops in egg passed in faeces. Infection by ingestion of embryo-containing eggs. Embryo-containing eggs contaminate fingers from crushing female Oxyuris in perineal region.
Helminthic Diseases. Cestodes
| Parasite | Defin. host | Intermediate host | Important reservoir of virus | Transmission and pathogenicity |
| Dibothriocephalus latus. | Man. | 1st, cyclops? 2d, fish. | Man (feces), dog and cats. | Eating raw fish containing pleocercoid larvae. Broad Russian tapeworm disease. |
| Hymenolepis nana. | Man. | Not required. | Children (feces). | Man intermediate and definitive host. Ingestive. Dwarf tapeworm disease. |
| Taenia saginata. | Man. | Cattle (ox). | Man (feces). | Eating insufficiently cooked beef containing cysticerci. Ingestive. Beef tapeworm disease. |
| Taenia solium. | Man. | Hog. | Man (feces). | Eating insufficiently cooked pork containing cysticerci. Ingestion. Pork tapeworm disease. |
| Taenia echinococcus. | Dog. | Man, sheep and hogs. | Dog (feces). | Dogs infected at abattoir. Hydatid disease. |
Note.—Rare cestodes of man are (1) Dipylidium caninum. A parasite of the dog with louse or flea as intermediate host. (2) Hymenolepis diminuta. A parasite of rats. Intermediate host in insects. (3) Species of Davainea. Intermediate host possibly cockroach. These cestodes are probably accidental parasites of man.
Arthropodan Diseases
| Parasite | Life history | Disease and manifestations and remarks |
| Linguatula serrata (Linguatulidae). | Adult in nasal cavity of dogs, etc. Eggs in nasal mucus contaminate grass. Rabbits, cattle infected. Larvae in liver, lungs. | Porocephaliasis. Man may harbor adult or larva. Larvae usually in lungs or liver and do not seem to cause symptoms. |
| Porocephalus armillatus (Linguatulidae). | Adults in lungs of snakes. Eggs contaminate water or food. Larvae in liver, lungs, etc., of lions, monkeys, man, etc. | Porocephaliasis. Larvae wander in abdominal cavity or lungs in which latter they produce a chronic bronchitis which may resemble phthisis. |
| Demodex folliculorum (Demodicidae). | All stages passed within hair follicles or sebaceous cysts especially about nose. Adult may wander. | Demodectic acariasis. Causes a resistant itch in dogs. In man, may invade eyelids or meibomian glands, and has been reported as causing various forms of dermatitis. |
| Sarcoptes scabei (Sarcoptidae). | Female lives in burrow of skin giving off eggs which hatch into larvae. | Scabies. Burrows show as blackish lines, especially between fingers, flexor surfaces of arms and penis. Itching worse at night. |
| Pediculoides ventricosus (Tarsonemidae). | Female lives on wheat straw worm or grain moth. Larval mites develop inside mother. | Grain itch. The mites leave wheat straw or grain and attack harvesters or those sleeping on straw mattresses. Attack upper trunk, neck and arms. Erythematous or vesicular eruption with constitutional symptoms. |
| Microtrombidium pusillum (Trombidoidae). | Adults live in fields or woods. The larval mite lives on grasshoppers or small rodents. | Autumnal erythema. The larval mites known as red bug or jigger attack man causing a severe itch. |
| Dermanyssus gallinae (Gamasidae). | Mites live in chicken houses and feed on fowls. | Poultryman’s itch. The mites attack man producing eczematous dermatitis on backs of hands and forearms. |
| Dermacentor venustus (Ixodidae). | Adults live on cattle, sheep, etc. May bite man. | Tick paralysis. The bite of this tick or Ixodes holocyclus may produce paralysis in sheep. An ascending type of paralysis due to tick bites has been several times noted in man, chiefly in children. |
| Pediculus humanus (Insecta, Pediculidae). | Adults live on clothing or hair and feed on man. | Pediculosis—Phthiriasis. Produce skin irritation with later on pigmentation (Vagabondismus). |
| Dermatophilus penetrans. (Sarcopsyllidae). | Impregnated female penetrates skin of man or animals, especially toes and feet. | Sandflea or chigoe infestation. Site of penetration shows as black spot with whitish induration surrounding it. Apt to form ulcers. |
Arthropodan Diseases (Continued)
| Parasite | Life history | Disease and manifestations and remarks |
| Dermatobia cyaniventris (Oestridae: Bot Flies). | Eggs of fly become attached to mosquitoes or ticks. These latter bite man and larva penetrates skin. | A cutaneous myiasis. Larva at first club shaped (ver macaque), later worm shaped (torcel). Larva causes a swelling with black opening. May invade eye. |
| Hypoderma lineata (Oestridae). | Larvae of this or other flies burrow under skin. | Creeping eruption. Larva migrans. The burrows make zig-zag lines on face or soles of feet. Causes itching. |
| Chrysomyia macellaria, and C. dux Muscidae). Oestrus ovis (Oestridae). | Fly deposits eggs in nostrils. Larvae wander to nasal sinuses. May invade aural canal. | Screw worm infection. Nasal myiasis. Larvae in their wandering destroy tissues of nasal cavities, or of ear, and may cause death. May infest wounds or vagina. C. macellaria causes American nasal myiasis, C. dux causes Indian nasal myiasis and O. ovis causes African nasal myiasis. |
| Ochromyia (Cordylobia) anthropophaga (Muscidae). | An African fly, which deposits eggs on children and animals. | Larvae bore under skin, causing boil-like lesions with central opening. Larvae mature in two weeks. |
| Auchmeromyia luteola (Muscidae). | An African fly deposits eggs on floors of native huts. Larvae bite man. | Congo floor maggot. The bite is not painful. |
| Calliphora vomitoria and Lucilia caesar and L. serricata (Muscidae). | Blow and bluebottle flies, depositing eggs on tainted meats. Larvae may be found in feces. | Larvae may be cause of obscure abdominal conditions; may be found in nasal cavities, causing serious symptoms, or in ear. |
| Musca domestica (Muscidae). | Eggs presumably deposited near genitalia or ear. | Larvae have been found in male urethra and in the ear. |
| Sarcophaga carnaria (Sarcophagidae). | Viviparous. Larvae are deposited on decaying flesh (wounds, orifices of body). | Larvae gain access to wounds, nasal cavities, etc., at times causing death. Commonly found in intestinal myiases. May occur in vagina. |
| Anthomyia pluvialis (Anthomyidae). | Larvae deposited in body orifices. | Occasionally reported as found in ear. |
| Fannia canicularis (Anthomyidae). | Eggs deposited near external genitalia and larva penetrates urethra. | Symptoms of urinary irritation or obstruction. Has been found in gastro-intestinal tract. |
SECTION V
INFECTIOUS GRANULOMATA OF THE TROPICS
CHAPTER XXVI
YAWS OR FRAMBOESIA
History and Geographical Distribution
History.—Some authorities think that a disease described by the Arabian physicians of the 10th century was yaws, but the first description of what was undoubtedly yaws was that of Oviedo, who in the 16th century described such an affection as existing in the West Indies. Bontius, later on, noted the existence of the disease in the East Indies as well as in the West Indies.
It is known that yaws often occurred in epidemic form on board the slave ships and it is thought that this disease may have been an African importation into the new world.
Geographical Distribution.—Yaws is essentially a disease of tropical regions.
In Africa it is very prevalent in the equatorial region, especially in the Congo Free State. It is also found more rarely in Tripoli and Algiers and to a less extent in the Sudan region. It is common in the West Indies and tropical America.
In Asia it is very prevalent in the Malay Peninsula, Siam, the East Indian Islands and in the Philippines. It does not exist in Japan. In many of the islands of the Pacific it is exceedingly prevalent, particularly in Samoa. It is also present in Northern Australia.
Etiology and Epidemiology
Etiology.—In view of the fact that many great authorities, especially J. Hutchinson, insisted upon the syphilitic nature of yaws it was a matter of great interest when Castellani, in 1905, discovered the causative organism which is characterized by the same sharp-cut, corkscrew spirals[385] that are noted with the syphilitic spirochaete discovered by Schaudinn in the same year. Treponema pertenue is found in the epidermis of the yaws granuloma and has been demonstrated in lymphatic glands and spleen. Although it has not been demonstrated in the blood, through microscopical examination, it must exist there as monkeys infected with the blood of yaws patients develop the lesions of yaws in which the spirochaetes are present. Another name for the organism is Spirochaeta pallidula; this however is only a synonym.
Inoculation experiments as well as clinical manifestations show yaws and syphilis to be distinct. Thus Charlouis, in 1881, inoculated a native suffering from typical yaws wistations of syphilis followed. There have been many instances of the development of yaws, naturally and by inoculation, in those affected with syphilis. Nichols has shown that a rabbit which had been infected intratesticularly with T. pallidum and then cured by salvarsan did not show immunity to T. pertenue when the latter was used to infect the testicle.
In the monkey inoculation over the eyebrow gives a flat dry and scaly lesion with syphilitic material while yaws inoculation gives a softer, more oedematous one.
Levaditi and Nattan Larrier have noted that monkeys which had been inoculated with syphilis were immune to yaws inoculation but yaws monkeys could be infected with syphilis, thus indicating that yaws was a mild form of syphilis. In Guam, it has recently been shown that 68% of cases of gangosa, a disease supposed to be a tertiary form of yaws, give a positive luetin reaction. This would indicate a close relationship between yaws and syphilis.
Salvarsan is more specific for yaws than it is for syphilis and the percentage of positive Wassermann tests is as great in yaws as in syphilis.
Notwithstanding the above points, which would indicate a close relationship, all authorities are now agreed that clinical and pathological evidence show the two diseases to be separate entities.
Epidemiology.—Charlouis inoculated 32 Chinese prisoners with scrapings from yaws lesions. The disease developed in 28 of them, first showing itself at the site of inoculation.
Paulet inoculated 14 negroes with yaws material and after a period of incubation of from twelve to twenty days a primary lesion appeared, to be followed by the generalized eruption. In naturally acquired yaws the period of incubation is from three to six weeks. These experiments are in line with the known fact that any skin abrasion which comes in contact with a yaws lesion becomes infected, as when the mother nurses an infant with lesions on its face and develops a yaws lesion at the site of some fissure about the nipple.
Yaws shows a striking limitation to the tropics and in a disease so communicable by direct contact it seems remarkable that it does not spread from the occasional case introduced into temperate regions. In the tropical world it seems limited to low level areas. Another feature of yaws epidemiology is the vastly greater susceptibility of colored races, even those of mixed white blood showing a certain degree of immunity.
All evidence is against a congenital form of yaws.
In particular are flies important factors in the transmission of the disease, transferring the secretions from yaws lesions to abrasions or ulcers on the skin of healthy persons.
The greater the attention to personal hygiene the less probable is the spread of yaws, so that Europeans are rarely infected while the disease may be prevalent in the native population.
In countries where it is prevalent it is chiefly a disease of children, the adults possessing immunity as the result of attacks in childhood.
Pathology
The primary yaws lesion is histologically the same as the lesions of the generalized eruption of the second stage. In these lesions we fail to find the endothelial proliferations and perivascular round cell infiltrations so characteristic of syphilis. There is great thickening of the interpapillary pegs of the epidermis which dip down deeply into the corium. Areas are noted in the epithelium containing swollen degenerated epithelial cells, polymorphonuclears and granular débris. There is marked oedema in the corium with dilatation of the blood vessels and lymphatics.
There is less oedema of the corium in yaws than in a syphilitic condyloma thus accounting for the greater dryness of the former. The main point in the pathology of a yaws lesion is the predominating involvement of the epidermis and the comparatively slight change in the corium.
In a Levaditi-stained specimen the spirochaetes are found in the epidermal layers instead of in the corium as with syphilis.
The visceral organs and central nervous system are not affected although Harper has reported cases of tabes and general paresis in Fijians following yaws. He excludes syphilis.
Symptomatology
It is usual to consider the clinical course of yaws as exhibiting two stages, the primary one, which comes on from 2 to 5 weeks after introduction of the virus and is characterized by a papular initial lesion, which later shows the fungoid appearance of a typical yaws tubercle, and the secondary stage in which yaws lesions similar to the initial one develop as a generalized eruption.
Some authorities recognize a tertiary stage in which gumma-like nodules, with subsequent ulceration, appear. There is much evidence to indicate that a destructive ulceration of the nasopharyngeal region, in natives of Guam, is a tertiary manifestation of yaws.

The Primary Stage.—During a period of incubation, averaging three weeks, vague digestive troubles, nocturnal headache, joint pains and an irregular fever may be noted which often abate upon the appearance of the initial papule at the site of inoculation. There may be enlargement and tenderness of the lymphatic glands about the time of the appearance of the eruption. This initial lesion may be single or there may be several papules grouped together. In some cases it may be impossible to get any history of a primary lesion or it may have been overlooked. The primary lesion is almost invariably extra-genital and it has the same appearance as the lesions of the secondary stage, thus differing from syphilis.

The yaws lesion, whether primary or secondary, starts as a papule which in a few days enlarges to the size of a small pea. It is conical and surrounded by an inflammatory areola. At this time the thickened epidermis begins to crack and a yellowish sero-purulent fluid exudes from the underlying fungoid base. They bleed easily but are not painful. It is this fungoid yellowish or yellowish-red tubercle which has been thought to resemble a raspberry, hence the name framboesia. French authors liken it to a fig which has been turned inside out. The moist or crusting surface soon shows an underlying ulcer, which may dry up leaving a pigmented spot or become exuberant and appear as a mass of fungating granulations, 1 to 2 inches in diameter. Such lesions are given the name “mother yaw.”
The Secondary Stage.—In from six weeks to three months after the appearance of the initial lesion, which may have dried up and left only a scar, or which more commonly is still present, there again set in malaise, headache and joint pains with an irregular inconstant fever.
The secondary eruption is made up of lesions having the same character and course as the primary yaws tubercle. In the general eruption, the papules appear frequently in the region of the junction of skin and mucous membrane as about mouth, nose and anus. In such regions they may become very moist and resemble the mucous patches of syphilis.
Besides their location on face and about the perineal region they are numerous on neck, arms, legs, and buttocks. They are rare on the trunk and scalp.
In their ordinary locations the yaws tubercles are not painful unless pressed firmly but when located on the palms of the hands or soles of the feet the thick skin of these regions exerts pressure so that in such situations the lesions are painful.
In this stage yaws does not involve mucous membranes or affect the viscera.
The secondary stage lasts from 3 or 4 months to 2 or 3 years, the yaws tubercles coming out in successive crops in long standing cases.
The Tertiary Stage.—Daniels noted in the Fiji Islands destructive lesions of the naso-pharyngeal region which he thought might be associated with a preceding yaws attack. He noted cutaneous lesions which resembled lupus vulgaris. Boissiere has noted not only the nasopharyngeal lesions and lupus-vulgaris-like ones but also tibial involvement, joint swellings and dactylitis.
Numa Rat describes various tertiary manifestations. There may be subcutaneous nodules about ankle or leg which soften and may produce bone lesions and deformities. He notes destructive lesions of nares, pharynx and palate which may[390] set in years after an attack of yaws. His description of the process starting as an ozoena or sore throat followed by destruction of the uvula, velum palati and septum nasi is much like gangosa. Howard has noted the greater frequency of destructive lesions of the nasopharynx in those parts of Africa where yaws is prevalent than in parts where syphilis prevails.

According to Castellani the characteristic lesions of tertiary yaws are gummatous nodules and deep ulcerations. Such ulcerations may give rise to contractures.
In Guam the view now prevails that the condition known as gangosa is a form of tertiary yaws.
Other than a moderate anaemia there is very little in the blood of yaws which differs from the normal.
Peculiar Types of Yaws.—When yaws tubercles develop in the palms of the hands or soles of the feet we have a very painful and incapacitating condition resulting. The pressure of the thick unyielding epidermis on the tubercles beneath gives rise to marked pain, thus differing from tubercles on other parts of the body. Eventually these tubercles break through and the affected sole may have a worm-eaten appearance. The name “crab yaws” is a common one for such a condition involving the soles of the feet and is so-called from the difficulty in walking which has a resemblance to the locomotion of a crab. In some cases the yaws tubercles adjoin one another to form a circle enclosing unaffected skin. Such an arrangement of lesions is often described under the name of “ringworm yaws.”

Diagnosis
Clinical Diagnosis.—Bromide eruptions may greatly resemble yaws but the history of the taking of the drug and the effect upon withdrawal should differentiate.
Syphilis and Yaws.—Degorce gives a very complete table of the points of difference between syphilis and yaws, some of the more important of which are the following:
| Yaws | Syphilis |
| 1. Primary lesion of soft consistency, or very little infiltrated, with granulating or pimply surface, situated almost invariably extragenitally, resembling the secondary lesions. Lymphadenitis not marked. | 1. Primary lesion infiltrated and indurated, with flat and smooth surface, ordinarily situated on the genital organs; often accompanied by abundant lymphadenitis. Phagedenic processes frequent. |
| 2. Roseola resembling that of syphilis but rarer. | 2. Roseola present. |
| 3. Secondary cutaneous lesions at first in the form of conical elevations of a light red color, not infiltrated at base, appearing in close groups. The lesions are similar to those of syphilis, namely, on the scalp in the form of encrusted papules; on thin-skinned regions in the form of ulcerating papules, and in the case of the palm of the hands and plantar surface of the feet, in the form of simple papules. | 3. Secondary cutaneous lesions papular from the first, dark red, infiltrated and fairly regularly scattered. |
| 4. Circinate lesions with the edges more raised than in syphilis, covered with yellow crusts. | 4. Circinate lesions with pink edges, slightly raised, with fine scales. |
| 5. On the face lesions of the same type, but more striking and with irregular projections. | 5. Seborrheic syphilides on the face. |
| 6. Cutaneous lesions do not itch. | 6. Cutaneous lesions do not itch. |
| 7. Perionychia similar to that of syphilis, but occasionally giving rise to pimply lesions. | 7. Perionychia present. |
| 8. Alopecia has not been described. | 8. In syphilis, alopecia rather the exception. |
| 9. Lesions in the buccal and pharyngeal mucosa often absent. No erythema. No typical mucous patches. Sometimes fissures at the angles of the mouth. The typical lesions are raised, pure white and occasionally covered with intact epithelium. | 9. Lesions in the buccal and pharyngeal mucosa are not numerous and are slight in degree. Erythema of the soft palate and pharynx occurs. Mucous patches. Ulcers of the lips and at the angles of the mouth. |
| 10. Lesions with prominent edges or even pustular with yellowish crusts, occasionally also ulcerations resembling mucous patches. | 10. In the glans, prepuce or vulva, the lesions are more or less typical mucous patches. |
| 11. Similar condylomata, but larger and more raised. | 11. Moist condylomata at the margin of the anus. |
The authorities generally discuss extensively the points of distinction between yaws and syphilis. This is probably more connected with possible relationship than practical importance in diagnosis.
Laboratory Diagnosis.—The staining of the juice from yaws tubercles by the India ink method or with Giemsa’s stain is the usual procedure.
Baermann gives the percentage of positive Wassermann reactions in untreated, clinically positive cases, as 80 to 100%; in treated cases, 50%, and in the latent ones as from 35 to 40%. In an examination of the serum of 281 cases of gangosa, Halton obtained 37.3% positive Wassermann reactions. Kerr found that 73.8% of 2,429 natives of Guam had had yaws, usually in childhood.
Among other diseases which may be confused with yaws, particularly as regards the nasopharyngeal ulcerations of tertiary yaws, may be mentioned American cutaneous leishmaniasis. The differentiation rests in finding Leishmania tropica in such lesions.
Sections from a yaws tubercle treated and sectioned according to Levaditi’s method show the treponemata in the region of the thickened interpapillary pegs of the epidermis.
Prognosis
This is almost entirely favorable as regards danger to life. The death rate is approximately ½ of 1% and such fatalities generally occur in young children in whom secondary infections develop on the site of the ulcerating yaws lesions.
Prophylaxis and Treatment
Prophylaxis.—Daniels thinks the frequency of infection about the angles of the mouth, which frequently show fissures, is explained by the exchange of particles of food or other substances by children, thus transferring the infection.
Of course care should be taken to prevent articles of clothing contaminated with yaws discharges from acting as infecting agents.
The main point in prophylaxis is to prevent flies from having access to abrasions on the skin, so that all cuts or sores should be protected by dressings. The sound skin is a barrier to infection.
Treatment.—It can certainly be stated that in salvarsan we have an absolute specific for yaws, the results which obtain in a few days being almost miraculous when one considers the protracted normal course of the disease.
The drug is given intravenously although neosalvarsan intramuscularly is more convenient for those not prepared to give intravenous injections.
The methods of administration are exactly as for the treatment of syphilis. The drug gives best results when used early in the course of the disease.
Doses of 0.4 gram of salvarsan usually suffice and frequently one dose effects a cure. The dose for women, children and thin individuals should be less than for strong adult men. Atoxyl does not seem to be effective in yaws. In other words the methods of treatment are the same for the two treponemata, except that the effect of salvarsan may be termed specific for yaws and less so for syphilis. Bergen found that about 4% of cases treated with salvarsan or neosalvarsan relapsed. The average time to effect a cure was eleven days.
Many of the older writers have reported the value of mercury in the treatment of yaws but the present view is that this drug has very little if any place in the therapy of the disease. Potassium iodide does seem to be a very useful drug in the absence of opportunity for obtaining some arsphenamine product. Where the specific remedy cannot be secured the next best treatment is Castellani’s yaws mixture. The formula for the preparation is the following:
| Tartar emetic | one grain | (0.06 gm.) |
| Potassium iodide | twenty grains | (1.3 gms.) |
| Sodium salicylate | ten grains | (0.6 gm.) |
| Sodium bicarbonate | fifteen grains | (1 gm.) |
| Chloroform water and syrup | one ounce | (30 cc.) |
The above is a single dose and it is given well diluted about three times daily. This treatment is continued for about a week and after an interval of another week is resumed according to the response to such treatment. In children between seven and fifteen years the dose is reduced one-half and for younger children correspondingly. It would seem well to start treatment with a smaller dosage than the standard one, being guided by the ability of the patient to stand an increase in the dose of the drugs.
For local treatment use antiseptic dusting powders as iodoform or boric acid.
CHAPTER XXVII
GANGOSA
History and Geographical Distribution
History.—It is known that in 1828 a Spanish Commission, investigating the diseases of the Ladrone Islands, reported the existence, in those islands, of a disease which was called gangosa, by reason of the muffled character of the voice, the Spanish word gangosa meaning muffled voice. The Commission recommended that cases of this disease, as well as those with leprosy, be isolated, thus showing that the disease was differentiated from leprosy at that time.
Daniels, who studied similar naso-pharyngeal lesions in Fiji, considered the disease as a sequel of yaws and stated that if it were not a stage of yaws it was probably a separate and distinct disease. Leys, who studied gangosa in Guam, in 1904, gave it the name rhino-pharyngitis mutilans and described it as a disease sui generis.
Geographical Distribution.—The disease is very prevalent in Guam, and is also present in other islands of the Caroline group. It exists in Fiji and many cases have been reported by Numa Rat from the island of Dominica, in the West Indies. Cases have also been reported from the Philippines and Ceylon.
Etiology and Epidemiology
Etiology.—The two most prominent views as to its etiology are that it is a sequel of either yaws or syphilis. The fact that gangosa responds to antisyphilitic treatment is no proof as to its luetic origin because yaws yields equally well to such remedies.
Gangosa cases also give a considerable percentage of positive Wassermann reactions, 105 positives in 281 cases. Halton who made these tests found 100% positive reactions in cases of yaws and 46% of positives in those who had had yaws several years previously.
The main points against the syphilitic nature of the disease are absence of either congenital or acquired syphilis among the natives of Guam. There is an absence of Hutchinson’s teeth and interstitial keratitis. Leys states that neither primary nor secondary syphilis had been seen in a native of Guam during a year in which a very large number, including several prostitutes, had been treated. Recently a positive luetin reaction has been obtained in 253 out of 369 cases of gangosa, of which 143[396] were papular type reactions, 65 pustular and 45 torpid reactions (taking ten days or more for the reaction to manifest itself). The syphilitic and yaws antigens seem to be reciprocal so that these tests do not throw out yaws. The great stumbling block of the advocates of the luetic etiology has been to show the presence of syphilis among the people of Guam. Under tropical ulcer it will be noted that Jeanselme failed to find the eye or teeth signs of congenital syphilis among natives of Indo-China with the disease.

Kerr, who has been an advocate of the yaws etiology, has shown that of 315 cases of gangosa, 205 could show yaws scars and knew where the mother yaw had been and of the entire 315 only 18 claimed never to have had yaws and failed to show scars.
Rossiter, who observed active ulcerations of the nasal septum and hard palate in the case of a two-year old Samoan child, following yaws, states that he found yaws treponemata in smears from the ulcerated areas.
Epidemiology.—If gangosa is a sequel of yaws then the same factors which are operative for yaws apply to gangosa.
Pathology
Sections made from the ulcerating margins of the nasopharyngeal lesions have failed to show treponemata when stained by Levaditi’s method. In sections of such tissue stained by Giemsa’s method I noted a rather marked infiltration with lymphocytes and a great number of mast cells. Fordyce has noted the presence of giant cells.
From the histological study one can only state that the lesions present the characteristics of the granulomata.
A remarkable feature of the disease is the rapidity with which ulceration destroys cartilage and bone. The nasal duct seems to be prone to attack and it is through this channel that the process reaches the eye to bring about its destructive tendency in that organ.
Of 81 cases studied by McLean and Mink the eye was involved in 21. The larynx was involved in 33 of these cases. It is the frequent perforation of the hard palate that gives these patients the nasal voice, whence the name of the disease is derived.
Symptomatology
Patients with the disease have rarely been observed prior to the full development of the mutilating ulcerations. In a few cases, however, it was noted that a patch of membrane first appeared in the region of the soft palate. This membrane rapidly became honeycombed and an examination three or four days later showed underneath a deep ulcer, surrounded by an area of marked congestion.
The ulcerating process advances rapidly, destroying bone as well as soft parts. The process seems to extend from within outward, giving a funnel-shaped loss of tissue. The ulceration advances upward and forward, destroying the nasal septum and structures forming the tip of the nose, leaving the upper lip as the lower border of this external opening.
The active process tends to become quiescent in one or two years, the cases then showing extensive loss of tissue with cicatricial borders.[398] Occasionally active ulceration may again set in after a period of quiescence.
The voice character is that of any case where there is a perforation of the hard palate and is not distinctive of the victims of this disease.
During active ulceration there is a malodorous sero-purulent discharge which makes the patients very objectionable. These cases seem to suffer very little impairment of the general health even when the process is active.
Although the destructive lesions about the nasopharynx and the region of the face are the most striking ones it would appear that similar ulcers on the extremities are of the same nature as those more prominently situated.
In an examination of the blood of 10 of these cases in Guam I did not observe any abnormal findings, other than an eosinophilia, which was present to an equal degree in those unaffected. Musgrave and Marshall reported a slight leucocytosis in their case.
Diagnosis
Gangosa is chiefly to be differentiated from leprosy, syphilis and lupus vulgaris. Its more rapid course should distinguish it from leprosy and lupus and the history from syphilis.
Treatment
Odell found that a thorough antisyphilitic treatment cured these ulcerations. He used mercurial injections. Recently salvarsan has been used with striking curative results. It has been thought that local application of tincture of iodine was effective in stopping the progress of the early ulcerations but this would seem doubtful, it being advisable immediately to give salvarsan.
On account of the offensive odor of the discharge solutions of permanganate of potash have generally been used.
CHAPTER XXVIII
MYCETOMA
General Remarks
Various destructive processes of different parts of the body, but more commonly of the foot, which are caused by invasion and growth of fungi are generally designated mycetomas. Chalmers and Archibald have studied these conditions most carefully and have grouped most of them under maduro-mycoses and actinomycoses. The mycetomas are characterized by the presence of fungi in the form of grains composed of hyphae, and at times chlamydospores, imbedded in a matrix. These grains may be imbedded in the tissues or present in the discharge from the sinuses. Eosinophile bodies are usually present. The maduro-mycoses have grains with large segmented mycelial filaments, possessing well defined walls and usually chlamydospores. We have white or yellow, black and red ones according to the colour of the grains. The actinomycoses have very fine nonsegmented mycelial filaments with ill-defined walls and no chlamydospores. We have black, yellow and red grain actinomycoses. In addition to the mycetomas we recognize paramycetomas and pseudomycetomas, the former of which show fungi which do not show any grain formation and the latter failing to have present either fungi or eosinophile bodies. The pseudomycetomas are associated only by reason of clinical resemblance.
History and Geographical Distribution
History.—The disease was first described by Kaempfer about 200 years ago, but at that time was often confused with elephantiasis. The first exact clinical description of the disease, with its pathology, in which was noted the fungus nature of the granules given off in the discharges from the sinuses, was that of Vandyke Carter, whose studies were carried on from forty to fifty years ago.
Geographical Distribution.—The name Madura foot takes its origin from the great prevalence of the affection about Madura, in the Madras Presidency of India. It is less frequent in other parts of India. It also occurs in Ceylon. The disease is rather widespread in Africa, having been reported from Algiers, Tripoli, Tunis, Egypt and the Sudan as well as from Madagascar. Cases have also been reported[400] from Italy and Greece in Europe and from the West Indies and some of the South American countries. Several cases have been reported from North America and Sutton, in 1913, reported two cases from Kansas, one in a Mexican and one in a native of Texas.
Etiology and Epidemiology
Etiology.—The disease is caused by the penetration of certain species of fungi into the tissues of the foot, although rarely the hand or some other part of the body may be affected. These species of fungus develop in granulomatous areas from which sinuses lead to the surface of the foot, in the discharges from which are found small granules resembling those found in the discharges from actinomycosis lesions.
As a rule only one kind of fungus is found in a single case. The most common infection is that due to Discomyces madurae (Nocardia madurae) which is the fungus of the fish-roe-like granules of the pale or white variety of mycetoma. These, like the fungus of actinomycosis, Discomyces bovis, show a felted mycelium in the center and peripheral club-like structures. These granules are yellowish-white and vary in size from a pin’s head to a small pea. The mycelial threads are very narrow, 1 to 1½ microns. It grows aerobically and the cultures show slender mycelial threads which are Gram-positive. This is the organism of Carter’s white mycetoma.
Other species of the pale, white or ochroid group of mycetoma fungi are Indiella mansoni (Brumpt’s white mycetoma), Nocardia asteroides (Musgrave and Clegg’s white mycetoma), Sterigmatocystis nidulans (Nicolle’s white mycetoma) and several others.
The cases caused by the black varieties are more rare and are characterized by the presence in the discharges from the sinuses of black gunpowder-like grains.
These hard, brittle, irregular grains are caused by various species of fungi of which the best known is Carter’s black mycetoma (Madurella mycetomi). This species was cultured by Wright and first shows a grayish growth, later becoming black. Other black varieties of mycetoma are due to various other fungi. Bouffard’s black variety is caused by Aspergillus bouffardi. DeBeurmann’s black mycetoma has as cause Sporotrichum beurmanni.
Besides the white and black varieties we also have a red variety of mycetoma. The fungus grains are quite small and reddish in color. It is not an uncommon infection in certain parts of Africa, as Senegal. The cause is Nocardia pelletieri.
Boyd and Crutchfield have noted an ascomycete in an American case, with white granules, to which has been given the name Alleschiria boydii.
Epidemiology.—We know very little about the occurrence of these mycetoma fungi, other than in man. It is thought that such fungi lead a saprophytic existence on thorns or blades of grass or spine-like grains of various cereals. Thus Nicolle’s case in Tunis started from a puncture wound by a grain of barley.
As the vast majority of such cases are noted in the feet, and as such cases are chiefly in those who work barefooted, it seems reasonable to consider that the fungi are introduced on some puncturing object and the external wound having healed development goes on in the deeper structures.
Pathology
In more than 75% of cases of mycetoma the foot is the only part infected. More rarely there is involvement of hands, knees and buttocks.
The affected part shows nodules on the external surface which connect with the granulomatous lesions of the interior of the foot by sinuses. In advanced cases there may be a network of sinuses and cyst-like dilatations which are filled with a viscid fluid packed with the small fish-roe granules in the white variety or the gunpowder grains of the black mycetoma. The bony structures of the foot may undergo disintegration as well as muscular and areolar tissue so that on cutting into such a foot there is nothing normal remaining—simply a cheesy mass.
In the early granulomatous areas are found the actinomyces-like granules surrounded by an area of mononuclear and polymorphonuclear infiltration. Giant cells are occasionally found. There is an inflammatory oedema. Externally we have connective tissue cells and a fibrous wall. The blood vessels show endothelial proliferation and thrombosis.
Symptomatology
The disease usually begins in the sole of the foot with the formation of firm swellings about ½ inch in diameter. The cases are rarely seen at this stage, the natives waiting before seeking medical advice until the nodule has softened and begun to discharge the viscid fluid with the various-colored granules floating in it. As stated before, the soft, yellowish-white, fish-roe-like granules are most commonly observed, the more friable, hard, gunpowder-like grains less so. The nodules continue to form and to break down until the foot has become greatly enlarged, the under surface bulging out in a convex mass with the toes and heels appearing as if raised up. The dorsal surface is also puffed up and studded with broken down nodules, and the sides well rounded. There is no increase in the length of the foot. This swollen distorted foot is borne on a thin peg-like leg which makes the size of the foot more striking. Very rarely cases have been reported where the hand or thigh have been involved.
If one probes the discharging sinuses bone may or may not be felt according to the advancement of the degenerative changes. There is rarely pain or bleeding following the probing.
It is more from the onerous burden of carrying around this fungoid[402] mass of a foot, 3 or 4 times the normal size, than pain, that the patient complains of.

Uncomplicated cases do not show fever and the occasional enlargement of lymphatic glands is probably connected with bacterial infections.
There are never visceral metastases in mycetoma as is true of the nearly related actinomycosis.
The process shows no tendency to heal naturally or under treatment but fortunately does not extend, the process being confined to a foot or a hand. The joints are rarely if ever invaded. Unless the sinus-riddled member is amputated the drain on the patient gradually exhausts him and death ensues in ten or fifteen years.
Diagnosis
The distorted appearance of the foot or hand, riddled with sinuses discharging a viscid fluid containing the variously colored granules, which upon microscopical examination are found to be sclerotia of fungi, is absolutely diagnostic. As regards recognition of the causative fungus one should culture the discharge or grains on maltose agar, potato or rather dry blood serum. The recognition of species of fungi is a very difficult matter, even for an expert.
Prognosis
This is absolutely unfavorable as regards the relief of the condition but as regards life it is not unfavorable provided the drain on the system is gotten rid of by amputation of the part.
Prophylaxis and Treatment
Prophylaxis.—The wearing of shoes in the fields or forests would seem to be the best means of protection against small wounds from thorns, splinters and the like.
Then, too, any such wound which might occur should be treated with tincture of iodine.

Treatment.—It is usual to try the effects of curetting the lesions and if taken early enough this may have effect. As a rule the process goes on but is limited to the member attacked so that amputation of the diseased part brings about a cure. Iodide of potash is of no value. X-ray treatment seems to be of value in relieving the pain and in lessening the discharge from the sinuses but is of questionable curative effect. It might be of greater value if tried early in the disease.
CHAPTER XXIX
GRANULOMA VENEREUM
History and Geographical Distribution
History.—It is generally stated that Daniels first noted the disease in British Guiana, in 1896, but Daniels regards the disease previously described by Macleod from India under the designation “serpiginous ulceration of the genitals,” as referring to granuloma venereum.
Geographical Distribution.—Cases of the disease have been chiefly reported from British Guiana and the West Indies. It is now recognized, however, that it occurs in India, China and Northern Australia as well as in some of the islands of the Pacific. It also occurs in Northern and Central Africa.
Grindon has reported 3 cases from the United States.
Etiology
Various spirochaetes have been reported as present in the lesions. The finding by Wise of spirochaetes resembling Treponema pallidum has not been generally accepted.
Donovan has reported the presence, in scrapings from the ulcerations, of an oval bacillus (1½ × 2 microns) which was contained in large phagocytic cells. There were sometimes several such bodies in a single cell.
Flu has recently reported the presence in plasma cells as well as occasionally in other cells of a capsulated organism which he believes related to the Friedlander group. His cultural work has not been conclusive. It is probable that this capsulated organism is merely a secondary invader.
There is also a suggestion of the cellular reaction characteristic of the chlamydozoa.
The disease is rather more common in women than in men and is rarely seen before the period of puberty. It is thought that it is transmitted by sexual intercourse.
Pathology
The pathological process manifests itself as a small round cell infiltration of the superficial portion of the corium. The growth is well supplied with blood vessels. Giant cell formation and caseation have not been noted. There is an abundance of plasma cells.
There is a marked tendency to the formation of fibrous tissue.
Symptomatology
The disease usually first shows itself as a papule or vesicle on the penis or labia minora. The process extends and the thin epidermal layer rubs off leaving a surface of granulations which bleed easily and give off a creamy discharge which is frequently very offensive.

The process usually extends from the penis to the groins by continuity and thence down the inner surfaces of the thigh. When the glans penis is involved there may be a fungating growth suggestive of epithelioma. In the female the process extends from the labia minora into the vagina and also to the labia majora and thence to[406] the perineum and perianal region. Recto-vaginal fistulae often result. The process extends more rapidly and markedly when invading mucous membranes.
While the granulomatous process is advancing there is frequently cicatrization of the areas previously invaded forming a scar tissue which breaks down easily. There is little pain or itching and the general health is not impaired.
There is no enlargement of the lymphatic glands. Although the process extends by continuity yet it may also pass to parts in contact with the diseased area. While healing of affected skin tends to occur that of mucous membrane does not.
There is really very little tendency to ulceration.
Diagnosis
It is usual to suspect a syphilitic process but the absence of gland involvement and secondary manifestations of syphilis negatives this.
It may be suggestive of tuberculous or epitheliomatous processes. The marked chronicity and tendency to scarring are striking.
Treatment
Excision of the entire granulomatous area going well into the normal skin has been thought by some to be the only cure.
Ordinary antisyphilitic treatment does not seem to have any effect and the good reports that have been made as to therapeutic success with salvarsan may have been due to diagnosing a syphilitic process as granuloma venereum. Radiotherapy has been recommended.
Local treatment with antiseptic or deodorant washes or ointments is necessary in these cases.
Antimony Treatment.—Breinl reports success in treatment by using tartar emetic injections. This treatment is now the standard one and the drug is given intravenously as described under treatment of leishmaniasis. It is also recommended to apply locally compresses soaked with a ½% solution of tartar emetic.
SECTION VI
TROPICAL SKIN DISEASES
CHAPTER XXX
TROPICAL ULCER
General Considerations
Under the names tropical phagedaena or tropical ulcer various skin lesions have been described, from all parts of the tropics, which vary greatly in etiology and symptomatology.
These skin ulcers are most frequently observed on the dorsum of the foot or front of the leg but may appear on the hands or forearms and have rarely been reported from other parts of the body.
There is no doubt but that many of the cases reported as tropical ulcer are really manifestations of tertiary syphilis.
Jeanselme has noted the insignificant manifestations of the secondary stage of syphilis in natives of Indo-China and the malignancy of the tertiary ones as regards the skin lesions. In fact a striking feature of the late stages of syphilis in the natives of the tropical world is the frequency and severity of skin lesions and the rarity or absence of involvement of the central nervous system to produce tabes or general paresis.
Again congenital syphilis is common in most tropical countries which have been visited by white men for long periods and Jeanselme has noted the rarity in natives so affected of interstitial keratitis and Hutchinson’s teeth, signs upon which medical men are apt to base a diagnosis of such a condition.
Again, Butler, studying the serological side of 27 ulcerations which clinically could be diagnosed as tropical ulcer, obtained strongly positive Wassermann tests in 26, or 96 per cent. of the cases. Shattuck found that about 94% of the chronic ulcerations of the Philippines could be ascribed to syphilis.
Besides syphilis one must bear in mind the possibility of the ulcers being a manifestation of tertiary yaws, a condition which also gives a high percentage of positive Wassermann tests.
In Guam, the natives separate the ulcerations about the lower extremities from the naso-pharyngeal ones by designating the former cases llagosos and the latter[408] gangosas. It is probable that the leg ulcers are manifestations of the same disease as the naso-pharyngeal ones whether it be syphilis or yaws. These ulcers of the leg in Guam as well as those studied by Butler in the Philippines would certainly be classed as tropical ulcers.
There are undoubtedly many cases which can be explained by infections with ordinary pyogenic organisms of the skin which are enabled to get a foothold in an abrasion or other minor wound, in a person whose resistance has been reduced by such cachexia-producing diseases as malaria, dysentery or ancylostomiasis.
Indeed some authorities attach special importance to the tibial ulcers found in advanced cases of hookworm disease. Some of the sores are due to irritating applications used by the natives of many countries as setons. In many instances the sores are from neglected wounds.
Vincent has called attention to the association of the fusiform bacillus and delicate spirillum, better known in connection with Vincent’s angina, in smears from tropical ulcers.
Such findings have also caused many to consider tropical ulcer as related to hospital gangrene. There is no doubt but that smears from the dirty membranous deposit on these ulcers do frequently show the fusiform bacillus and at times the spirillum, but we also frequently find various fungi in such smears. Very few hold that these have anything to do with the production of the ulcer.
Inoculation experiments have as a rule been indefinite in result.
LeDantec has incriminated a very large Gram-negative bacillus which was noncultivable.
Prowazek believes that he has found the cause in a spirochaete which possesses fewer turns and these more widely separated than those of the spirochaete of syphilis. The association with the fusiform bacillus has also been noted.
Wolbach and Todd note the frequent finding of spirochaetes in tropical ulcers and attach considerable importance to a spirochaete with abruptly tapering ends. The name of Spirochaeta schaudinni has been given to the organism. They also generally found associated micrococci and bacilli as well as the fusiform bacillus.
Other than the noting of granulation tissue and the presence of plasma and small round cells there does not seem to be anything definite in the histopathology of tropical ulcer. This is what one might expect in view of the lack of definite knowledge of the condition.
Veld sore.—Under the name of Veld sore we have a form of tropical ulcer which is common in various desert regions.
These ulcerations may appear on the face as well as on the dorsal surfaces of the hands or forearms or on the lower extremities. They seem to arise from infections of abrasions of the exposed parts. In the early stages of the lesion the diphtheria bacillus has been frequently isolated and some of the cases have been followed by diphtheritic palsies. It would appear that these lesions have at times been those of[409] cutaneous diphtheria. Such cases were reported by Craig in cases in the Sinai desert. The simultaneous existence of cases of ordinary faucial diphtheria should make one suspicious of the real nature of such ulcerations. Skin diphtheria is more frequent than is generally considered.
Symptomatology
These ulcers are most frequently found on the dorsum of the foot, over the shin and about the external malleolus. More rarely they involve the dorsum of the hand or back of the wrist.
In the multiplicity of clinical descriptions from various parts of the tropics we obtain two types of ulceration.
One is that of a rather chronic ulcer, which slowly develops from a painless swelling, which is not unlike a gummatous process. Surrounding the swelling there is a circumscribed, reddened, glazed area of skin. After two or three weeks the swelling begins to soften and a serous fluid exudes from its summit.
Ulceration, with the frequent formation of a membrane-like deposit, now sets in and later on we have a more or less punched-out ulcer showing indurated margins. There may be no impairment in the health of those with this type of ulcer.
The other type is generally seen in persons who are much debilitated or suffering from some cachectic state. In the earliest stages these sores seem to resemble an area which has been excoriated and inoculated with vaccine virus, there being a rather dry, angry-looking spot of erythema. This within a few hours may be surrounded by a circle of vesicles beyond which is an encircling inflammatory areola.
There is marked subjective pain and tenderness. The serum from the vesicles fails to show any bacteria and the cellular contents are made up almost entirely of polymorphonuclear leucocytes. Within a few hours to one or two days the area within the ring of vesicles is converted into a dark gray to black pultaceous diphtheroid membrane which when detached shows underlying fungating granulations, covered with greenish-yellow pus. This membrane, if stripped off, tends to reform with great rapidity (twenty-four to forty-eight hours), and in many respects resembles the membrane of diphtheria except for its dark color.
These ulcerations extend with great rapidity and even when showing a tendency to heal may suddenly, from a point along the margin, proceed to form a new area of ulceration, extending somewhat as would a ringworm. When the original site of ulceration fails to heal during a period of several weeks, the edges become rather indurated but do not show the punched-out or undermined characteristics of the first type.
These cases last for months and are far more tantalizing than the former type of[410] ulceration for the reason that from time to time they show a strong tendency to heal, the process clearing up almost entirely, when suddenly the former area of the ulceration is equalled or exceeded.
Treatment
Many of these ulcerations yield readily to salvarsan and in such cases we naturally think of a syphilitic or framboesial etiology.
Castellani has recommended a protargol ointment, 5 to 10%, which is applied to the ulcer after previous flushing with hydrogen peroxide or other antiseptic lotion.
At times thorough cauterization with pure carbolic acid followed by neutralization with alcohol may shorten the process.
Iodide of potash benefits some cases but has no effect on others and the same is true of mercurial treatment.
An 8% ointment of scarlet red should be tried on these sores when treatment with ordinary applications fails.
CHAPTER XXXI
TINEA IMBRICATA
General Considerations
This form of tropical ringworm is chiefly found in the islands of the South Pacific and in the Malay Archipelago. It is also found in Southern China and quite recently has extended to Southern India and Ceylon. Recently it has been reported from Brazil.
On account of the disease having been carried from the Tokelau Group to Samoa it is often designated tokelau.
Manson was the first to recognize the affection as due to a fungus which he demonstrated microscopically in the scales.
He was also able to transmit the disease by inoculation experiments and found that after about ten days a raised, brownish spot appeared at the site of inoculation. This spot increased in size until when about ¼ inch in diameter its central portion became detached, thus giving rise to several thin, rosette-like scales, free at the center but still attached peripherally. The fungus advances peripherally, leaving a smooth surface within. Again there is a similar process developing in the original central spot to again form a circle of scales within the older and more peripheral circle. The process is repeated until several rings of scales are formed each originating from the central focus as concentric ripples form on water from the fall of a pebble.
These scale circles are from ⅛ to ½ inch apart and give a festooned appearance to the affected skin. It was formerly supposed that the causative fungus was Aspergillus concentricus but Castellani has demonstrated that fungi of this genus, when present, are merely accidental. He has isolated in cultures what he considers the causative fungus, Endodermophyton concentricum. He treated scales for ten minutes with absolute alcohol and then placed single scales in a series of tubes of maltose bouillon.
The fungus grows between the rete malpighii and the external epidermal layers forming a network of mycelial threads, about 3 microns broad.
Another fungus cultured from tinea imbricata scales is Endodermophyton indicum. Inoculation of this organism in pure culture produced the disease.
The characteristics of the genus Endodermophyton are: The growth of a mycelial network between the rete malpighii and the superficial epidermal layers; in cultures only mycelial filaments are found; there are no conidia-bearing hyphae.
The fungus is also called Trichophyton concentricum.
When this skin disease is introduced into a country with high relative humidity and fairly uniform temperature, between 80° and 90°F. it spreads with great rapidity.
A dry climate or one showing considerable variations in temperature is not favorable for its spread.
Symptomatology

Fig. 129.—Tinea imbricata from the South Seas. (After Kramen; from Mense.)
The clinical characteristic of this form of ringworm is the presence of rosette-like lesions of several concentric circles of shingle-like, papery scales which are fixed peripherally and free toward the center, thus, from its imbrications, suggesting the name given it by Manson.
If one passes the finger over the affected surface from without inward there is no sensation of roughness but if passed from the center outward the free borders of scales cause a sensation of roughness.
As these circles extend peripherally they meet the peripheral rings of other circles so that various curves appear which give the general appearance of watered silk.
The flaky scales are of tissue paper thinness and are of a dirty, brownish-gray color.
The general health of the patient is not affected but the itching is very severe.
There is an entire absence of inflammation about this ringworm thus differentiating it from the more common tropical ringworms.[413] Again the axillae and crotch are much more rarely affected than in other ringworms as is also true of the face, palms of hands and soles of feet. The scalp is never affected.
Some claim that the fungus never invades the nails but Manson states that this frequently occurs. The presence of the fungus in a scale treated with 10% solution of sodium hydrate differentiates the scales from those of ichthyosis.
Tinea intersecta is somewhat similar to tinea imbricata when first appearing, showing dark brown patches but it never shows the concentric rings. The ordinary ringworms present inflammatory characteristics.
Treatment
A thorough preliminary scrubbing with soap and water in order better to expose the fungus to curative applications is important.
For treatment Manson recommends iodine liniment. This contains 12½% of iodine as against 7% for the tincture. The liniment has also 3½% of glycerine which is not an ingredient of the tincture. Both tincture and liniment have 5% of potassium iodide. The application of the tincture does not seem to be as satisfactory as the liniment, the stronger preparation being more effective.
Chrysarobin is very effective but very irritant and has to be used with care. An application of a 5% solution of chrysarobin in chloroform to the affected area, then painting it over with a 50% aqueous solution of ichthyol, often gives good results.
Some prefer a 2% to 5% ointment of chrysarobin. Chrysarobin produces a conjunctivitis if used near the eyes. Again if absorbed it may act as a renal irritant.
Castellani strongly recommends the use of resorcin in tincture of benzoin (60 to 120 grains of resorcin in 1 ounce of tincture of benzoin). Either remedy alone has very little effect, the combination being necessary. The application is made once or twice daily. In addition to this treatment the patient should be scrubbed with sand-soap and hot water twice a week.
As regards prophylaxis the clothing should be boiled. The natives attach value in preventing the disease to anointing the body with cocoanut oil.
CHAPTER XXXII
TINEA CRURIS
General Considerations
Under the name “dhobie itch” this fungus affection is probably better known to Europeans than any other tropical skin disease. This name dhobie or washerman’s itch has been given on account of associating it with the infection of the underclothing while being washed in the pools or streams along with the garments of those who have this skin disease. This, like every other widespread view, has probably some foundation but cannot be verified. It is the eczema marginatum of Hebra.
This affection is caused by various species of Epidermophyton. This genus differs from Trichophyton in that it never invades the hair or hair follicles.
The species which have been more frequently reported are Epidermophyton cruris, E. perneti and E. rubrum. The mycelium is about 4 microns broad and the spores about 5 or 6 microns. All of these fungi can be cultured on Sabouraud’s maltose agar, growth appearing in about a week, except E. perneti, which grows more rapidly.
Symptomatology
The favorite site is the crotch although the axillary region is also frequently involved. The process starts as a papule but these rapidly develop and give rise to an angry red, swollen patch with sharply delimited margins. These red, festooned patches are usually limited to the perineum, scrotum and inner surfaces of the thighs.
The itching is unbearable and many secondary infections or eczematous lesions result from the fierce scratching of the parts.
If the patient goes to a cooler place the process subsides to return when he comes back to the hot moist climate where the infection was originally contracted.
In some cases the fungus invades the region between the toes and gives rise to intolerable itching and from secondary bacterial infections to a condition known as “Mango toe.”
It has seemed to me that when one has a coccal infection engrafted upon the fungus one the condition becomes what might be termed fulminating, so rapidly does the itch extend.
Treatment
When the process is markedly inflammatory mild applications are indicated, such as calamine lotion (30 grains each of calamine and zinc oxide with 5 or 10 drops of carbolic acid in 1 ounce of saturated solution of boric acid).
A 10% to 15% solution of sodium hyposulphite can, however, be used on the area even when markedly inflammatory.
Iodine applications are too irritating for the region of the scrotum.
An ointment of resorcin, 20 to 30 grains with 1 dram of sulphur to the ounce, may be tried. If chrysarobin be used it should be applied with greatest care as noted under tinea imbricata. Many advocate applications of solutions of salicylic acid in alcohol, 2% to 5%.
Manson’s dusting powder of equal parts of boric acid, zinc oxide and starch should be freely used.
CHAPTER XXXIII
PINTA
General Considerations
This is a parasitic skin affection due to various species of fungi. It is only found in the tropical portion of the new world, and is especially prevalent in Colombia, where it has been estimated 4% of the population have the disease. It is also found in Mexico, Central America and some of the other countries of South America as well as Colombia.
Other names for the disease are caraate and mal de los pintos. At first it was thought that the different colors shown by the eruption were due to varying depths of the proliferating fungi in the skin layers but it is now known that the explanation is in a variety of species in the different types of pinta.
The pure violet pinta is caused by Aspergillus pictor while the grayish-violet one is due to Penicillium montoyai. A species of Monilia causes the white variety and different species of Montoyella a black and a red variety respectively. The genus Montoyella is stated by Castellani to have both slender and thick mycelial threads, from the thicker of which spring delicate hyphae terminating in pear-shaped conidia.
Material scraped from the lesions and mounted in liquor potassae shows the fructification terminations characteristic of Aspergillus or Penicillium in the violet or gray-violet varieties while the white, black and red ones only show mycelial threads and scattered spores. These pinta species of fungi can be cultivated on Sabouraud’s medium.
Montoya thinks that the pinta fungi lead a saprophytic existence in the waters of mines or other places with a constant high temperature, and states that he has obtained pure cultures from such sources.
Symptomatology
The spots of the eruption are generally first noted on the hands or face and are rather rough, dry and only slightly raised. Itching is quite marked and the scratching probably is largely responsible for the gradual spread of the affection over the body generally.
The palms of the hands, soles of the feet and nails are never involved. The course is essentially chronic and shows no tendency to spontaneous cure.
The red pinta is that most often found in white people, the patches being of brick-red color.
The white pinta may not only be caused by a species of Monilia but it may represent an area formerly invaded by a species producing some other color and then dying out leaving a vitiligo-like area.
The violet pinta is quite common among miners, while the black one is the type which more often appears in the black population. The black varieties may show either a pure black or a violet-black color.
Treatment
Local applications of iodine preparations or of chrysarobin seem most effective. The resorcin sulphur ointment noted under tinea cruris is best for the face.
CHAPTER XXXIV
MINOR TROPICAL AFFECTIONS OF THE SKIN
Dermatophiliasis
This is a skin infection due to the penetration of the region about the feet and especially the toes by the female sand flea or chigoe. It is also sometimes called the jigger. This flea is a member of the subfamily Sarcopsyllinae which differs from the ordinary flea subfamily in that the impregnated female becomes fixed in the tissues of the host instead of developing her eggs in a free state. The proper name for this flea is Dermatophilus penetrans, synonym Sarcopsylla penetrans. It is found abundantly in Central America and Northern South America as well as in the West Indies. It is also found in East and West Africa as well as India and is apparently rapidly spreading over the tropical world.

This flea attacks not only man but many wild and domesticated animals as well, and in particular the pig. The males and females live in dry sandy soil and feed on the blood of various mammals. The importance of the parasite is that upon[419] impregnation the female ceases to lead a free existence but burrows into the tissues of man or other host and becomes enormously distended with eggs. There is some question as to whether these eggs are extruded by the female or whether they are set free in the ulceration process which tends to occur around the imbedded flea. The eggs develop into 13-segment larvae, which form a cocoon from which the insect comes out in about ten days.

Fig. 132.—Sandflea female. Shortly after penetrating the skin. The anterior part of the abdomen is much more distended than the posterior; the enlarged part is disk-shaped, not globular. (From Mense.)
The female flea tends to burrow into the skin about the sides of the toe nails, although more rarely boring into other parts of the body as penis, scrotum, thighs or hands. Finally only the tip of the abdomen projects. This marks the black spot which is noted in the tense itching area which is quite white unless bacterial infection starts up inflammation.
The swelling is about the size of a small pea by the end of five or six days. Ulceration is the usual termination of the infection if untreated and such ulcers may be very intractable or form a favorable soil for infection with the tetanus bacillus. Quiros has estimated that 250 deaths from tetanus occurred in Costa Rica in 4 years from infection of nigua (sand flea) ulcerations.
Well-made shoes are most important in prophylaxis and the best treatment is to enucleate the egg-distended flea with a needle and then touch the cavity with pure carbolic acid followed by neutralization with alcohol. It is astonishing how expert the natives become in dissecting out these insects.
Tropical Impetigo
Under the designation pemphigus contagiosus Manson describes a very common skin disease of the tropics. The condition, however, is not pemphigus. A bacteriological examination shows in the smear great numbers of pus cells containing phagocytized diplococci. Wherry has named the organism Diplococcus pemphigi contagiosi. As a matter of fact, culturally, this organism is the common Staphylococcus pyogenes aureus.
It is also a matter of common observation that this organism when in pus cells of active inflammatory processes shows a diplococcus morphology rather than a staphylococcal one.
These staphylococcal lesions which do not start in the hair follicles are often designated as “pyoses.”
The disease is markedly contagious in children and is strikingly autoinoculable so that unless the first lesion is taken in hand immediately the eruption may become generalized. A small spot of erythema first appears which rapidly becomes vesicular, the bleb covering the entire spot, so that there is practically no surrounding inflammatory areola.
The diaphanous covering rubs off with the slightest touch and leaves underneath a raw-looking surface which extends peripherally to form an angry-looking red patch an inch or more in diameter. In adults it rarely affects parts other than the axilla or crotch.
The general health of the child is practically unaffected.
The usual treatment is with bichloride lotions followed by a dusting powder of equal parts of boric acid, starch and zinc oxide. I have found, however, that an ointment of ammoniated mercury, 2% to 5% according to age, is the most satisfactory treatment.
Tropical Boils.—It is interesting that the same organism responsible for this more fulminating lesion should be the one responsible for the common cosmopolitan boil and in fact boils are exceedingly common in the tropics. These boils may be larger and with a greater tendency to widespread distribution and in some regions they are so common as to have a regional designation (Nile boils). The staphylococcus of tropical impetigo seems to have greater virulence than that of the boils. Autogenous vaccines are often most successful in the treatment of boils.
Piedra
This is a fungus disease of the hairs in which small nodules form along the shaft. They are about the size of the nits of head lice but more or less surround the hair instead of projecting off at an angle as do the ovoid lice nits. These little masses are black in color and very hard, hence the name piedra—stone. The disease is chiefly found in Colombia and is thought to be due to the application, by the women, of a mucilaginous preparation to their hair. If an infected hair be examined in liquor potassae the nodule will be found to be made up of faceted bodies matted to the side of or, at times, encircling the hair. These bodies are the spores of Trichosporum giganteum.
Besides piedra there are also other nodular affections of the hairs due to species of Nocardia. Chalmers has recently reported several cases of trichonocardiasis where the axillary hairs were matted together and the skin of the region inflamed. Castellani called attention to this condition in 1911 and reported a narrow, bacillus-like fungus as the cause, Nocardia tenuis. The nodules are rather soft and may be yellow, black or red in color. Microscopical examination shows the fungus.
Chalmers had excellent results by treating the affected hairs with a 2% formalin solution in alcohol. At night a 2% ointment of sulphur was applied. A 5% alcoholic solution of salicylic acid has also been recommended.

Fig. 133.—Insects in which the larval stage is important. (1) Chrysomyia macellaria; (2) larva; (3) Dermatobia cyaniventris larva, early stage (ver macaque); (4) D. cyaniventris larva, later stage (torcel or berne); (5) D. cyaniventris; (6) Auchmeromyia luteola; (7) A. luteola, larva; (8) Sarcophaga magnifica; (9) S. magnifica larva; (10) Anthomyia pluvialis; (11) A. pluvialis larva.
Cutaneous Myiases
Ver Macaque.—The best known of these myiases is that due to the larva of a botfly (Oestridae), Dermatobia cyaniventris.
The larva is at first club shaped and in this stage is called ver macaque. Later on it becomes worm shaped and is then called torcel in Venezuela or berne in Brazil. The natives of most of the countries where the infection is found have called the larvae “mosquito worms” or “gusano de zancudo” and they have even incriminated large mosquitoes belonging to the genus Psorophora as being responsible for the infections.
Surcouf has noted that these fly larvae have been found cemented to mosquitoes of the genus Janthinosoma by a glue-like substance. These mosquitoes are vicious biters and evidently the young larvae escape from the eggs attached to the mosquito and enter the wound made by the biting parts of the mosquito. Some have thought that D. cyaniventris deposits its eggs in a glue-like material on the leaves of plants and that they stick to mosquitoes flying about such plants. From the facts that these eggs apparently only become attached to this particular mosquito, and further in that the eggs are attached in a constant manner with the hatching end outward, it would seem that the mother fly must in some way seize the mosquito and deposit her eggs on it. As the larva grows in the subcutaneous tissues of man or other animals a tumor-like swelling develops with a central orifice, toward which the posterior extremity of the larva points and through which it takes air into its spiracles.
It has been stated that the eggs of D. cyaniventris may be conveyed by ticks.
The swelling somewhat resembles a blind boil and may be as large as a pigeon’s egg.
These botfly boils tend to break down and discharge a sero-purulent fluid and it is supposed that the larva, when mature, escapes as a result of the disintegration of the tumor.
In Brazil they make tobacco juice applications which cause the larva to protrude and then squeeze it out. The injection of a little chloroform into the larva with a hypodermic syringe, prior to its extraction with a forceps, makes the process less painful.
The Screw Worm.—This is the larva of a bluebottle fly, Chrysomyia macellaria, which differs from the common bluebottle fly, Lucilia, by having 3 black lines on scutum. This muscid fly lays 200 to 300 eggs in wounds or orifices having offensive discharges, as from nose, ears, etc. The larvae burrow into the adjacent tissues and cause frightful destruction of all soft parts. The mature larvae are a little more than ⅔ inch long and have circlets of spines around each of the 12 segments.
This infection is especially common in tropical and subtropical America and is important in animals as well as man.
In Yount’s 23 cases 18 were of nasal myiasis; the mortality for the 23 cases was 15% and for the nasal ones 22%. Irrigation with chloroform water or a 5% carbolic acid or compound cresol solution gives the best results in treatment. If the larvae reach the sinuses it may be necessary to open them to get at the parasites.
Creeping Eruption
This is a skin affection which is also called larva migrans on account of its being due to the burrowing of more or less undetermined fly[423] larvae in the subcutaneous tissues. In their advance, which is at the rate of from one to several inches daily, they leave a raised pinkish line. The burrow is approximately ⅙ inch in diameter. The disease is most common in Southern Russia but is also found in Africa, Asia and South America. Looss considers that hookworm larvae, when penetrating the skin, may produce similar lesions.

Fig. 134.—Wing venation of Diptera. A, first posterior cell; B, discal mid cross-vein; a, auxiliary vein; C, marginal cell; D, submarginal cell. In the illustration of the Chrysops wing, the letter “B,” indicating the discal cell, is misplaced. It should be in the same relative position as in the Tabanus wing.
Tumbu Fly Disease
This African myiasis is due to the penetration of thighs or buttocks by the larvae of Cordylobia anthropophaga. The appearance of the tumefied area is quite similar to that of the tumor of Dermatobia cyaniventris and the treatment is similar.
Craw-craw
This is a rather chronic papular skin disease which is reported from the west coast of Africa. These papules may be as large as a small pea and are quite hard. They are found chiefly on legs and arms. The proximal lymphatic glands may be enlarged.

Fig. 135.—Markings of breathing slits on posterior stigmata of various larvae. 1. Musca domestica, showing both stigmata; 2. Calliphora vomitoria; 3. Stomoxys calcitrans; 4. Auchmeromyia luteola; 5. Cordylobia anthropophaga; 6. Sarcophaga magnifica.
Undoubtedly many of the cases called craw-craw are scabies. In fact the Africans give the name to a host of different skin affections. O’Niel thought he had found a filarial larva in one of his cases and Nielly incriminated a nematode larva of the Anguillulidae family. The cause is unknown and the disease very intractable to treatment.
SECTION VII
TROPICAL DISEASES OF DISPUTED NATURE OR
MINOR IMPORTANCE
CHAPTER XXXV
VERRUGA PERUVIANA AND OROYA FEVER
It is thought that Oroya fever was the disease which proved so fatal to Pizarro’s army in the 16th century. In 1870, great interest was aroused in these diseases on account of their prevalence in the workmen constructing the railroad from Lima to Oroya, a town in the Andes. At this time there was much conflict of opinion as to whether the two diseases were identical. In 1885, Carrion, a medical student of Lima, inoculated himself with the blood from a verruga lesion and died from Oroya fever about one month later. As the result of this it seemed to be established that infection with verruga material would produce the serious first-stage fever and many call the fever Carrion’s disease. Consequently these two diseases have, until recently, been considered as two stages of the same disease, the usual idea being that Oroya fever is the first stage, following which, provided the patient does not die from this very fatal fever, there sets in an eruption which is the second or verruga stage. In order to reconcile the observations of the development of the eruptive stage without a severe, febrile, preliminary one of three or four weeks, it was considered that the first stage might be exceedingly mild.
Strong and his colleagues, however, inoculated a volunteer with material from verruga lesions and sixteen days later the eruption appeared without the preliminary fever and anaemia that are so characteristic of Oroya fever, and it is now recognized that they are two distinct entities.
OROYA FEVER
General Considerations
Oroya fever is an acute, infectious disease, often terminating fatally, caused by the Bartonella bacilliformis, and characterized by an insidious onset, irregular fever, pains in the bones and a rapidly developing anaemia of the pernicious anaemia type.
The disease is chiefly found in towns situated in narrow, wind-protected valleys of the west side of the Andes, at elevations of from 3000 to 9000 feet. Townsend has suggested that a species of Phlebotomus, P. verrucarum, which is very prevalent, may be the transmitting agent. This investigator believes that verruga and Oroya fever are the same disease. It may be stated that malaria and enteric fevers, as well as verruga, are common in the localities where Oroya fever prevails and much of the confusion in the literature of Oroya fever is due to failure to differentiate the better known conditions. Strong noted that Oroya fever was common from January to April, particularly towards the close of the warm, rainy season. Cases were rare in April and May and did not occur in the months of June, July and August. He notes that verruga was not uncommon at the time when Oroya fever was not occurring. Concomitant infection with Oroya fever and verruga may occur but this is also true of malaria or malaria and verruga may exist at the same time.
Barton isolated a paratyphoid bacillus from the blood of a patient, besides which other bacteria have also been isolated. In 1909, Barton noted certain rod-like organisms in the red cells of Oroya fever patients which he considered protozoal in nature.
Strong and his colleagues found in the blood of Oroya fever cases rod-shaped forms in the red cells, varying from 1 to 2 microns in length, the red cells containing from 1 to 30 of these elements.
A study of sections of lymphatic glands of severe fatal cases showed great numbers of these bodies packed in the endothelial cells. These cells rupture and set free the organisms.
Intravenous inoculation of blood containing these elements into monkeys and rabbits was negative in result. Strong failed to cultivate the organism. These organisms were considered as intermediate between bacteria and protozoa. They are closely related to Grahamella and the Harvard commission has proposed the name Bartonella bacilliformis. In many ways they resemble piroplasms, especially Theileria.
Pathology
At autopsy the skin shows the pale yellowish waxy hue of pernicious anaemia. The lymphatic glands are somewhat enlarged and may be oedematous. The heart is flabby and ecchymoses may be present in the pericardium. The spleen is enlarged, shows numerous infarctions and contains large amounts of pigment in the form of yellowish masses[427] or granules deposited between the splenic cells and in the endothelial leucocytes. This pigment is like melanin in not giving the iron reaction. The liver likewise is enlarged, shows areas of toxic degeneration and contains moderate amounts of pigment. The femoral marrow is soft and dark red. Microscopically, the endothelial cells of the lymphatics distended with the causative organisms were particularly noted by Strong.
Symptomatology
The incubation period is about three weeks and the onset of the disease is marked by malaise and apathy, to be followed by a rapidly developing anaemia, of the pernicious anaemia type, with an irregular fever of a remittent character fluctuating between 100° and 102°F. and only exceptionally going up to 104°F., and pains in head, joints and bones. The tenderness over the bones is undoubtedly associated with the marked changes going on in the bone marrow and is particularly marked over the sternum.
The patient rapidly develops a very severe anaemia and death results in 20 to 40% of cases in two or three weeks. Delirium is often noted.
The spleen and the lymphatic glands are somewhat enlarged. Associated with the profound anaemia there may be oedema of legs and about joints and functional cardiac murmurs. The kidneys do not seem to be affected. There may be a diarrhoea in the later stages of the disease. There is no eruption in uncomplicated cases.
The most important findings in the disease are those in connection with the blood examination. The rod-shaped organisms, which are thought to be the cause of the disease, are somewhat difficult to observe in fresh blood preparations. They show definite motility within the red cells, particularly after warming the blood slide. The motion is a rather gliding one. In Romanowsky-stained preparations the 1 to 2 micron-long rods within the red cells may occur singly or in numbers of 4 or 5. V-shapes are frequently seen. The rod shows a bluish staining with a deep purplish-red chromatin-stained granule at one extremity. Rounded, oval or pear-shaped forms may also be seen.
While the parasites are present in great numbers in severe cases they may be very scarce in mild forms of the disease.
Very striking is the rapidly developing anaemia which frequently shows a red cell count of less than a million within a few days. Normoblasts are quite numerous and fulminating cases show numerous megaloblasts.
Polychromatophilia and poikilocytosis are noted.
In the red cells we have the picture of a rapidly developing pernicious anaemia The color index is above 1.
The leucocytes number about 20,000 of which 60 to 70% are neutrophiles. Immature neutrophiles, as the metamyelocyte, are very common.
Prophylaxis and Treatment
The transmitting agent not being known we are in the dark as to prevention. Evidence points to some arthropod biting at night as the incidence of the disease decreased when those working in the Oroya fever zone were compelled to leave the valleys before sundown. The treatment is largely one of nursing although some have reported favorably from the intravenous administration of salvarsan.
VERRUGA PERUVIANA
General Considerations
Verruga peruviana is an infectious eruptive disease, caused by an unidentified virus, lasting two or three months, and characterized by successive eruptions exhibiting two types of lesion,—the miliary and the nodular,—both of which show a pronounced tendency to ulceration and haemorrhage. The eruption of verruga somewhat resembles that of yaws and it was at one time suggested that verruga was simply yaws as influenced by high altitude. Strong and his colleagues found that they could infect rabbits intratesticularly and that lesions resembling those of man could be produced in dogs and monkeys by cutaneous and subcutaneous inoculations. The virus has been transmitted from monkey to monkey. The monkey is not as susceptible to the virus as man and the rabbit and dog less so. Inoculation of the monkey is not followed by a generalized eruption. The Wassermann reaction was negative. In extracts from the granulomatous lesions they found a very active haemolysin. It will be remembered that animals are not susceptible to Oroya fever blood inoculations.
From the fact that it is possible to inoculate a person by rubbing verruga material on a scarified surface it would seem that the infection might be transmitted by insects.
As regards the pathology of verruga, Cole has noted involvement of the lymphatic channels, which become obstructed by a cellular exudate, around which lymphatics are found plasma cells and fibroblasts. There is marked dilatation of the capillary blood vessels. The[429] structure of these granulomatous tumors is very vascular, almost cavernous, hence the tendency to haemorrhage. The haemolysin may also be operative in the liability to haemorrhage.
Strong and his colleagues found the early lesions to consist of newly formed blood vessels lying in an oedematous connective tissue. The endothelial cells lining them may be in more than one layer. Around these blood vessels we have aggregations of cells which are considered as angioblasts. These angioblasts show frequent mitotic figures. There is a resemblance to a fibrosarcoma.
Symptomatology and Treatment
The period of incubation is about two weeks as shown by experimental inoculation but may be as long from the standpoint of clinical observation as forty days. At the onset we have rather severe pains of joints, especially the knees, ankles and wrists, together with a fever sometimes reaching 104°F. but usually not above 100°F. Following the eruption, the temperature usually subsides to normal in a few days. The eruption shows two types, the one with numerous, small, wart-like lesions, not exceeding the size of a small pea (2 to 5 mm.)—the miliary type, and the other, with less numerous but much larger nodular masses—the nodular type. The latter type is more rarely seen than the former.

The Miliary Type.—The eruption is most abundant on the face and extensor surfaces of the extremities and less common on the trunk. In this type a pink macule appears which rapidly takes on a bright red color and becomes nodular. These nodules may be flat or somewhat pedunculated and bleed easily. At first smooth and shiny, it later on shrivels up without leaving a scar. This form of the eruption may involve the mucous membranes, as of conjunctivae, nose, pharynx, etc. In children the disease is usually of a mild type.
The Nodular Type.—The nodular eruption develops slowly and the lesions may become as large as a pigeon’s egg. They tend to become strangulated and then show as ulcerating, fungating masses which are a source of danger from haemorrhage. The nodular eruption does not invade mucous membranes and is usually confined to the regions of joints, as flexures of elbows, knees, etc.
The eruptions tend to come out in crops and the duration of the disease extends over two or three months.
Treatment.—The ordinary principles of cleanliness apply to the care of the lesions to prevent secondary infections. When the large tumor-like masses begin to ulcerate or become gangrenous they should be excised. It must be remembered that dangerous bleeding may occur at unexpected times, for which reason the patients should be provided with styptics or compresses to prevent serious loss of blood.
CHAPTER XXXVI
DENGUE AND DENGUE-LIKE FEVERS
Definition and Synonyms
Definition.—Dengue is an epidemic disease due to an ultramicroscopic, filterable virus which has been stated to be transmitted by Culex fatigans. More recent work points to Stegomyia.
It is characterized by an initial three or four-day febrile paroxysm of very sudden onset, a remission, which comes on about the fourth day and a terminal rise of temperature for two or three days—the saddle-back temperature course.
Backache and pains about the muscular attachments at the joints and especially a marked postorbital soreness are important features.
An eruption appears about the third or fourth day. Leucopenia and polymorphonuclear reduction are constantly noted. Apathy and a mild neurasthenic state may continue into convalescence.
Synonyms.—Dandy Fever (the word dengue is supposed to be derived from the Spanish equivalent of dandy or denguero), Break-bone Fever, Bouquet. German. Dengue-fieber.
History and Geographical Distribution
History.—While Hirsch gives the credit for the first mention of the disease to the chronicler Gaberti, who described a disease with certain resemblances to dengue as existing in Cairo in 1779, yet, for the reason that certain clinical features of this epidemic would hardly appear to belong to dengue, as we now know it, there would seem to be good ground upon which to give the credit of priority to Benjamin Rush, who, under the designation break-bone fever, gave us a true picture of dengue as it manifested itself in Philadelphia in 1780.
Gaberti was particularly impressed with the knee involvement so that from his description the disease was known as the disease of the knees. He further noted swelling of the fingers and that the pains continued for more than a month. The sudden onset and the sweating would seem to belong to relapsing fever as well as to dengue and in support of the view that the disease described by Gaberti might have been relapsing fever we have the statement of Sandwith that bone pain, chiefly of the knee, is the symptom most complained of by the Egyptian native with relapsing fever.
Boylon, who reported an outbreak of an epidemic disease in Batavia in 1780 stated that everybody was attacked and that the symptoms were almost the same as those ushering in plague—headache, lassitude and pains in the joints. He noted, however, that this epidemic had no bad consequences, patients getting rid of it in three days under moderate diet and copious beverages.
Ashburn and Craig, in 1907, proved that the disease could be transmitted by injections of blood, unfiltered as well as filtered.
Geographical Distribution.—The disease may occur in epidemic form in almost any part of the tropical or subtropical world. It is very common in the countries about the China Sea and in the West Indies.
Etiology and Epidemiology
Etiology.—One can only state that the disease is caused by a filterable virus which is present in the patient’s blood from the second to the fifth day. Graham reported a piroplasm-like organism as the cause but other workers have failed to confirm this. Reports as to bacterial causative organisms have not been verified. Cleland and his colleagues inoculated guinea pigs and rabbits without result and were unable to find spirochaetes. Couvy has reported the presence of short spirochaetes in the blood 2 or 3 hours before the onset of the fever,—never later. They had two or three turns and fine extremities.
Epidemiology.—As regards the epidemiology of dengue there seems to be a general acceptance of the idea that dengue is transmitted by the common culicine mosquito of the tropics, Culex fatigans. There is not, however, that definiteness which attaches to the transmission of yellow fever by Stegomyia calopus or to pappataci fever by Phlebotomus papatasii, in both of which a certain period of development of the unknown filterable virus in the arthropod host is necessary before the insects become capable of transmitting the infections.
It will be remembered that in the nine experiments as to dengue transmission, conducted by Ashburn and Craig, the authors threw out five of the cases for such reasons as previous immunity or refusal of the experimental mosquitoes to bite. Of the four remaining volunteers only one developed dengue. This man, however, had been on duty at the Division Hospital in Manila and the statement is made that he had not been exposed to the disease so far as could be determined. This of course rather militates against the value of this isolated experiment and furthermore the mosquitoes which bit him had fed on the blood of a dengue patient only two nights previously. If this is to be considered as a valid experiment, we must believe that only a short sojourn of the virus in the mosquito is requisite, which is rather at variance with the twelve days for the yellow fever virus and eight days for that of pappataci fever.
In the recent Australian epidemic (1916) experiments failed to show C. fatigans capable of transmitting the disease. Stegomyia, however, gave success in 4 out of 7 cases, the volunteers developing dengue in from six to nine days after being bitten.
Stegomyia mosquitoes are often termed the domesticated ones, since they are observed to breed and pass their lives in the immediate environment of man and further to be distinctly urban, rather than rural, in their distribution. For their breeding places they choose artificial collections of water, such as cisterns, barrels, pails, bottles and cans, in or near dwellings.
These mosquitoes are small in size, silver-striped, vicious feeders and very alert. The female alone bites, blood apparently being necessary for ovulation. It feeds especially during the morning and afternoon hours,—much less commonly at night unless there is a light. The life history of Stegomyia is discussed more fully under yellow fever.
As regards the transmission of the disease by blood filtered through a diatomaceous filter it will be remembered that Ashburn and Craig, by proving this fact, placed the dengue virus in the same category with the filterable viruses of the two diseases just considered. Cleveland found the virus in the washed cells as well as in the serum. The virus maintains its potency for several days outside the body it being present in the blood at periods of from 18 to 90 hours.
Lavinder injected dengue blood from cases in the second to fifth day into rhesus monkeys without noting any variation in their temperature or blood findings.
Graham in Beirut carried out some experiments, one of which would seem almost positively to demonstrate mosquito transmission. He took mosquitoes which had fed on dengue patients, to a village in the mountains where no case of dengue existed. He caused these mosquitoes to feed on two natives of the village and both men became sick with dengue four and five days respectively after being bitten by the mosquitoes. Graham’s claims to have noted piroplasma-like organisms in dengue blood have not been verified and do not receive credence.
The most convincing evidence as to mosquito transmission of dengue is that afforded by the absence of dengue in Port Said during the years 1906 and 1907 notwithstanding the prevalence of the disease in adjacent parts of Egypt. This was attributed to the absence of mosquitoes, these having been destroyed in the fight to make Port Said malaria-free. This campaign was commenced in May, 1906.
Other species of culicine mosquitoes, among which may be noted Stegomyia, have been incriminated. In the Philippines I was convinced that Culex microannulatus might transmit the disease as well as C. fatigans. In one of his experiments Graham claimed to have produced dengue by injecting an emulsion of the salivary glands of a mosquito which had fed on a dengue patient one or two days previously.
Pathology
As death almost never occurs from the disease there is nothing to note other than the marked leucopenia.
Symptomatology
After a period of incubation of from four to fifteen days the disease manifests itself with striking suddenness, in fact the patient can generally recall almost the hour of the onset.
The temperature rapidly rises and in a few hours reaches a maximum of from 102° to 105°F. Associated with this primary fever we have frequently a blotchy congestion of the face—the so-called initial rash.
We also have intense headaches, principally supraorbital and postorbital. The pulse rate is slightly accelerated at first but soon becomes slow and may fall to 50 from the fourth to fifth day.
There is no involvement of the joints, and the so-called joint pains are really pains of the muscular insertions about the joints.
The backache of dengue is usually a well marked feature. Pain on motion of the eyeballs is a prominent symptom—it is a deep soreness.
Insomnia, characterized by frequent dropping off to sleep to be awakened immediately by disturbing dreams, is often noted.
The depression, mental and physical, is altogether out of proportion to the lack of seriousness of the disease.
Malaise and anorexia are marked. Constipation is the rule at first.
About the third or fourth day the temperature drops to normal or about that and remains so lowered for from twelve hours to three days. At this time the patient feels much better and views his affection in a less serious light. After this variable intermission the temperature rises to possibly a greater height than primarily, although as a rule it is less marked. This interval, or intermission, separating two periods of fever gives us a chart designated “saddle-back.” There may be only one rise of fever.
This second febrile attack is attended with pains and possibly greater depression than the first accession. It is usually, however, of shorter duration and during this period the terminal rash appears. This is the most characteristic feature of the disease. It generally manifests itself about the dorsal surface of hands and feet advancing up forearms and legs. Later on it may involve all extremities, face and trunk. The eruption is much like that of measles but lacks the dusky red appearance of the measles rash. It may however be punctiform and thus resemble the rash of scarlet fever.
With the appearance of the terminal rash we may have crises such as profuse sweating or marked diarrhoea or epistaxis.
The desquamation is furfuraceous in character and may be attended by marked itching.
In some patients (European) there is a rosy carmine flush of palms of hands and soles of feet. Some authorities have reported glandular enlargements in dengue.

Convalescence is apt to be protracted, being especially characterized by malaise and nervous depression, practically neurasthenia.
Leucopenia and polymorphonuclear percentage reduction appear by the second day.
Clinical Types.—In different epidemics it is noted that some one clinical feature may seem outstanding. Of these we may note:—
(1) The pulse rate is slow for the temperature rise, thus reproducing a phenomenon common in yellow fever (Faget’s law). It is in recent epidemics particularly that clinical descriptions have recorded the frequency of a very slow pulse, most of the older authorities having noted a pulse rate which corresponded to the elevation of temperature.
(2) In some epidemics the feature of glandular swelling is prominent, while in others the swelling is so slight as to be overlooked.
(3) The characteristic “saddle-back” temperature chart seems lacking in the general run of cases in certain outbreaks. It is possible that such epidemics, showing atypical temperature curves, may have been due to phlebotomus fever, or seven-day fever, instead of dengue.
(4) In some epidemics, the rash is insignificant or very slight in[436] most cases. This observation is possibly dependent on the ephemeral character of the eruption in certain groups of cases.
(5) From the chart Fig. 138, analyzing the symptoms in one epidemic, it will be noted that Lane observed cold, clammy, dusky extremities in 17 per cent of his cases. This is an unusual finding.
Symptoms in Detail
Onset and the Temperature Chart.—Dengue probably sets in more abruptly than any other disease. The temperature chart is typically saddle-back.
The Pains.—Very marked soreness deeply seated about the place of origin of the ocular muscles so that every movement of the eyeballs is at once complained of as giving pain.
General pains all over the body, more especially of the back and about tendinous insertions of the muscles which cause the pains to be referred to the joints. The knee-joint pains are probably the most frequent. The rachialgia may be as great as that in variola or yellow fever.
The Eruption.—The characteristic eruption does not appear until about the time of the intermission or with the accession of the terminal fever.
The fall of fever about the third or fourth day is often attended by a critical epistaxis, sweat or diarrhoea, to be succeeded by an intermission of from one to three days of a feeling of well-being. About this time or with the secondary rise of fever the true dengue rash appears. It is at first noted about the bases of the thumbs and extending over the dorsal surfaces of the wrists. Almost simultaneously a measles-like rash appears over the dorsal and internal surfaces of the big toe extending to the ankle, especially over the internal malleolus. Later on the elbows and knees may be involved or the rash may cover thickly the entire body. A carmine flush of the palms of the hands and soles of the feet is not uncommon. A furfuraceous desquamation with much itching at times follows the eruption. The so-called primary eruption is nothing more than an initial flushing of the face, it is ephemeral. The true dengue rash may also be quite ephemeral but usually it lasts for two or three days, or possibly four or five days.
The Nervous System.—Besides the headaches we have insomnia and depression which extends through convalescence. Apathy is marked.
The Blood.—This shows a leucopenia of about 4000 from shortly after the onset together with a reduction of the percentage of polymorphonuclears to about 45%. During the attack the eosinophiles are decreased but there is an increase during convalescence.
Diagnosis
The two diseases with which dengue can be most easily confused are influenza and yellow fever. In fact when the great pandemic of influenza (1890) first made its appearance in France, many regarded it as an atypical form of dengue.
CLINICAL CHART
ONE HUNDRED CASES OF DENGUE FEVER

The respiratory involvement of influenza and the eruption and comparatively slow pulse of dengue are the principal points of difference. It must be remembered that affections in the tropics, diagnosed as influenza, have shown but slight respiratory[438] symptoms, the cases being more of a nervous or intestinal type. The eruption of dengue may fail to appear or be missed in the study of the case. The blood findings should aid in differentiation from influenza as is also true of yellow fever, a disease which likewise has blood findings of practically a normal character. Other than the blood picture we have in yellow fever (1) albuminuria, coming on about the second day, and (2) jaundice appearing about the third day. In dengue the eruption appears from the third to the fifth day. Albuminuria is absent in dengue.
Dengue may be mistaken for measles, but the early coryza, Koplik spots and marked rash, first appearing about the face, should differentiate.
In scarlet fever the rapid pulse, angina and leucocytosis should be sufficiently differentiating.
Confusion with articular rheumatism may arise when the pain about wrists, knees and ankles has been mistaken for true joint involvement.
The headache and backache of smallpox may be confusing until the eruption about the forehead appears. The leucopenia of dengue is the main differential point in these first three days of doubt.
Prophylaxis and Treatment
Prophylaxis.—This would seem to rest entirely upon the question of destruction of mosquitoes and prevention of the mosquito from biting a patient. In dengue the virus is apparently in the blood for four or five days so that screening of patients is necessitated for a longer period than for yellow fever or phlebotomus fever.
Treatment.—The malaise and depression are generally so great that the patient keeps his bed voluntarily. A light diet is indicated although the anorexia is so marked that it is difficult to persuade a patient to take food.
Cold spongings, provided the patient is not disturbed by being moved, are of value for the insomnia. Phenacetine may be given for the relief of the headache and backache. It is rarely necessary to give morphine.
During convalescence tonics are indicated and if there is any condition where a good wine is of value, it is in this, to counteract the terrible depression. It has been suggested that adrenal insufficiency may account for the asthenic, protracted convalescence and from this standpoint adrenalin has been recommended.
DENGUE-LIKE FEVERS
Phlebotomus or Pappataci Fever
Etiology and Epidemiology.—This fever, which is often called three-day fever, on account of its running its course in this period, is caused by a filterable virus. This virus only seems to be in the blood of[439] the patient’s peripheral circulation during the first twenty-four hours of the illness, blood abstracted toward the end of the second day and injected into a well person failing to reproduce the disease.
If the blood is filtered through a Pasteur candle F, the filtrate will set up an attack just as well as the unfiltered blood, in this respect being like dengue and yellow fever. Couvy reports having found spirochaetes in the blood 3 hours and 24 hours after the onset.
The transmitting agent is a moth midge, Phlebotomus papatassii. This midge, as is true of the psychodid family, to which it belongs, is very hairy. It has long slender legs and narrow wings. The proboscis is as long as the head and the lancets project beyond the labium.
The female alone bites, which act takes place chiefly at night; cool, moist, shady places, away from sleeping rooms, being preferred in the day time. The insect is a persistent, vicious feeder, difficult to escape from, as mosquito nets offer no protection. It takes from six to eight days after feeding on a patient in the first day of the fever before the midge is capable of transmitting the disease, this being in accordance with the twelve-day developmental period in the mosquito, that holds for yellow fever. Doerr thinks that the pappataci virus may be transmitted hereditarily by the insect to the egg.
At present, of the genera of the three families of midges, only Phlebotomus is known to transmit disease. P. papatasii transmits phlebotomus fever in the Balkans. P. minutus is the host at Aden. Another species, P. perniciosus, can transmit the disease. These moth midges are 2 mm. in length and have the body densely covered with long yellow hairs. The second longitudinal vein has three distinct branches. The antennae have 16 restricted joints and the proboscis is as long as the head. The species of Phlebotomus are separated by slight variations in wing venation, palpal lengths, etc., thus the second segment of palpi of P. papatasii is a little longer than the third one, while with P. perniciosus these segments are of equal lengths. In P. minutus the second segment is only half the length of the third. The insect lays about 40 eggs in damp dark places. The period of metamorphosis from egg to insect is about one or two months, according to temperature.
Phlebotomus larvae die out in dry soil and very wet earth is unfavorable. Moderate moisture and protection from light seem necessary for their development. The remains of dead insects also seem to make good breeding places. It is in cracks of old damp brick or stone walls that the female most often deposits her eggs. Caves are also selected.
Blood seems necessary for the fertilization of the eggs but lizard blood seems more common in the stomach of P. minutus than human blood. They have also been observed to feed on other reptilian bloods. The female insect has been kept alive in captivity up to forty-six days.
Cases first appear in the late Spring and the disease becomes epidemic during the Summer.
An attack produces quite an immunity.
The disease has chiefly been studied in the Balkan States but undoubtedly it is widespread.
The disease is almost never fatal so that we know nothing of its pathology.
Symptomatology.—The symptoms will answer perfectly for cases of dengue one sees in a dengue epidemic in which, instead of the saddle-back course of fever, we have a three-day primary rise and then a fall to normal without any secondary fever rise. Cases of phlebotomus fever are occasionally reported where the fever continues seven or eight days.
The symptoms as usually given are as follows: After a period of incubation of from three to six days there is an abrupt onset with congested face and injected conjunctivae. There is pain in head, eyes and back. There is marked malaise with great depression of spirits. There is anorexia with coated tongue and rarely vomiting and diarrhoea. There may be some congestion of the pharynx and even a slight bronchitis. So much in common with influenza has it clinically that a synonym is summer influenza. The liver and spleen are normal. Mental depression is frequently noted. Epistaxis is rather common.
There is a leucopenia and polymorphonuclear percentage decrease. The two points which are chiefly advanced in its clinical differentiation from dengue are (1) slow pulse, a bradycardia, and (2) only three days of fever and absence of eruption.
Seven-day Fever
Rogers first described a dengue-like fever which occurred in India during the summer months as seven-day fever. The fever course was at times typically saddle-back and again would be of continuous type. A pulse relatively slow for the temperature is generally recorded, together with sudden onset and general malaise. The spleen is at times enlarged and there is a definite leucopenia and polynuclear percentage reduction. The eruption is only occasionally present (about 10%) and is an erythema which makes its appearance on the extensor surfaces of the forearm about the fourth day after the onset.
Etiology.—In cases similar clinically to the seven-day fever of Rogers, Ido, Ito and Wani have found a spirochaete resembling that of infectious jaundice and designated Leptospira hebdomadalis. It can be differentiated from L. icterohaemorrhagiae by immunity reactions. It is found in the blood during the fever period and young guinea pigs[441] can be infected by such blood either subcutaneously or by mouth. The organism can be cultured by Noguchi’s method. The spirochaete is to be found in the urine towards the end of the disease and the urine is probably the source of infection. In Japan field mice seem to be the carriers of this spirochaete. In about 3% of such rodents the spirochaete can be found in the urine and the disease is limited to the sections in which the field mice are found. There is practically no mortality and the treatment is symptomatic.
Sand-fly fever, and Three-day Fever
These dengue-like fevers of India are practically identical clinically with phlebotomus fever. The usual idea is that dengue epidemics are far more explosive in character than is true of epidemics transmitted by the sand-fly.
The strongest point in differentiation of sand-fly fever and dengue is that neither confers any immunity for the other disease.
The distinctions of enlarged glands and break-bone pains are often advanced as characteristic of dengue and not of sand-fly fever. I have never observed other than slight glandular enlargement in dengue cases.
Six-day Fever
Deeks has described a disease from Panama with a dengue-like clinical course.
There were but slight changes from normal in the pulse rate or blood findings. Some of the cases showed a late scarlatiniform eruption.
It was considered that the continuous fever for six days and the enlargement of the spleen, which accompanied the disease, differentiated it from dengue.
CHAPTER XXXVII
TSUTSUGAMUSHI
Definition and Synonyms
Definition.—This is an acute febrile disease caused by the bite of the larval Kedani mite of the region where the infection prevails. The onset is characterized by headache and giddiness, a rather rapidly rising temperature and swelling of the lymphatic glands draining the region in which is situated a small necrotic ulcer marking the site of the bite. With injected conjunctivae, continuous fever and hyperaesthesia, the disease goes on for about a week when a macular eruption appears about face, then chest, extremities and trunk. About ten days after the appearance of the eruption there is a fall of fever by lysis.

Synonyms.—Flood fever, Japanese River fever, Kedani mite disease. Shimamushi.
History and Geographical Distribution
History.—There are records which would indicate that the disease has been known for more than 1000 years.
Geographical Distribution.—It is only in the western part of the island of Nippon, when the banks of the Shinanogawa are inundated each spring, that we find the[443] disease. The disease is supposed to be confined to Japan although Ashburn and Craig have thought a disease observed by them in the Philippines as possibly identical.
Etiology and Epidemiology
The cause is unknown, but has been attributed by some to various bacteria and by others to a protozoon.
Nagayo attaches importance to piroplasm-like forms found in the spleen and lymphatic glands.
Kawamuro and his colleagues could not demonstrate any organism by any method of examination. The virus is in the blood and even as small an amount as 0.001 cc. may infect a monkey although 0.1 cc. is usually required. The virus is present also in the enlarged lymph glands. Heating the blood at 50°C. for 10 minutes destroys the virus. Recently Hayashi has reported as cause minute rod, ring-shaped or spheroid bodies which when stained with Giemsa’s stain are brought out in the lymphocytes and endothelial phagocytes of lymph nodes and spleen. They also occur in the blood plasma and in severe cases in red blood cells. He has transmitted the disease to monkeys, guinea pigs and rabbits. These bodies resemble bacteria, in this respect resembling the organisms of typhus and spotted fever of the Rocky Mountains. Hayashi regards the organism as resembling Theileria parva and Bartonella bacilliformis, and believes he has shown the field mouse to be a reservoir of the virus.
The disease is not communicable from person to person and only follows the bite of a larval mite, Trombidium akamushi (Leptotrombidium akamushi). This is a minute orange-red arachnoid which can scarcely be seen with the naked eye. This mite is only a source of danger in the region of the inundated river banks, its bite not producing the disease elsewhere.
Persons harvesting hemp during August are liable to contract the disease if bitten by the larval mite.
The mite is found in large numbers on the ears of field mice, these hosts, however, not appearing to be suffering from any particular disease.
Pathology
Other than the local ulcer and the swollen regional glands, there is little that is definite. The spleen shows enlargement and there is also swelling of the mesenteric glands. The lower part of the ileum may show injection.
Symptomatology
A Typical Case.—About one week after receiving the bite of the larval mite, which may not have been noticed by the patient, there develop chilliness, giddiness and headache, with a rising temperature. In two or three days from the onset, painful glands are noticed in[444] certain regions as of groin, axilla or neck. From these glands we can often by following inflamed lymphatics find the small necrotic ulcer which is often located in the armpit or in the region of the genitals. There is a dark red areola about the ulcer which is only slightly tender. The glands are not very much enlarged and are not excessively tender. There may be general glandular enlargement following that of the primary swellings. The pulse rate is only from 80-100, notwithstanding the rise of the fever to 104°F. or even 105°F.
The body is decidedly hyperaesthetic and the conjunctivae are injected. There is frequently deafness. About the seventh day a macular eruption appears first on the face and then spreads to chest, extremities and trunk. The eruption never becomes petechial. The tongue becomes dry and cracked. There is often a cough. The blood shows a leucopenia. The eruption disappears in from seven to ten days and the fever becomes remittent or intermittent and, after a few days, reaches normal. Parotitis may occur as a complication.
Schüffner has described a similar disease from Sumatra. The mortality is, however, only 3% as against the 30% in Japan. He thinks it is transmitted by a tick. In his cases the necrotic ulcer and glandular enlargements were followed by a roseola which reached its maximum on the eighth to tenth day and was most marked on the trunk and flanks. The nervous symptoms resembled typhoid fever and there was a lymphocytosis.
Symptoms in Detail
The Nervous System.—There is marked giddiness and headache at the onset. Hyperaesthesia of the body is quite characteristic. There is often delirium at night. Deafness is frequently noted.
The Cutaneous System.—A small necrotic ulcer about ⅙ inch in diameter, with a dusky red areola, is noted at the site of the bite of the larval mite. The healing of the ulcer is delayed well on into convalescence.
About one week after the onset a dusky macular eruption appears first on the face (cheeks), then going to the chest, legs, forearms and trunk. It is not marked on neck, arms or thighs. It never becomes petechial.
Fever Course.—The temperature, which on the first day or two reaches only 101° to 103°F., becomes later on higher and continuous. About the tenth day from the appearance of the eruption it begins to fall, becoming remittent and then intermittent.
The Lymphatic System.—Very characteristic is the swelling of the glands proximal to the initial ulcer. The connecting lymphatics may be inflamed. Later on other glands may show slight swelling and tenderness.
The spleen is usually enlarged.
The Blood.—There is no change in the red cells but there is a leucopenia.
Diagnosis
In the differential diagnosis the limited geographical distribution should prevent error and, in particular, where one has the initial necrotic ulcer, with enlargement of the glands draining the region in which it is located, there should be little confusion. Of course plague may have a primary vesicle or ulcer with enlargement of neighboring glands; these glands however are matted together and are exquisitely tender.
Then too the eruption of tsutsugamushi and the early and more stuporous state of plague should differentiate, even without the aid of the laboratory.
It is usual to consider tsutsugamushi, typhus fever and spotted fever of the Rocky Mountains as having many characteristics in common. These diseases may best be differentiated by the fever course and eruption as shown in the following table:
| Fever course | Eruption | |
| Tsutsugamushi | Fever increases each day until reaching maximum about 4th or 5th day. Fall by lysis after fading of eruption. | Begins on face, then chest, legs, forearms and trunk. Does not become petechial. First appears about 7th day. |
| Tabardillo. Typhus fever. Brill’s disease. | Onset and termination of fever characterized by considerable abruptness. | Begins on abdomen, sides of chest, thence going to extremities. Petechial tendency. First appears about 5th day. |
| Spotted fever of the Rocky Mountains. | Gradual rise during a week with lysis. | Begins on forearms and leg. Petechial tendency. May have gangrene of prepuce and scrotum. First appears on 2d to 5th day. |
Treatment
There is no specific treatment. It may be necessary to use drugs to combat the insomnia.
The serum of monkeys which have recovered from the disease seems to have some value.
CHAPTER XXXVIII
SPOTTED FEVER OF THE ROCKY MOUNTAINS
Definition and Synonyms
Definition.—The disease is chiefly reported from certain sections of the states of Montana and Idaho. The virus is not filterable and is probably bacterial in nature and is transmitted solely by the tick, Dermacentor andersoni, which arthropod host gets its infection from certain rodents of the section serving as virus reservoirs.
Maxey described the disease as follows: “An acute endemic, noncontagious, but probably infectious febrile disease, characterized clinically by a continuous moderately high fever, severe arthritic and muscular pains and a profuse, petechial eruption in the skin, appearing first on the ankles, wrists and forehead but rapidly spreading to all parts of the body.”
Synonyms.—Rocky Mountain fever. Tick fever of the Rocky Mountains. Black fever. Blue disease.
History and Geographical Distribution
History.—The disease was first noted in the Snake River Valley of Idaho, about 1893, and in the Bitter Root Valley of Montana, about 1890. There is some evidence that the disease may have existed among the Indians prior to the advent of white settlers in the Bitter Root Valley. The disease was first described by Doctor M. W. Wood, U. S. A., in 1896. It is interesting to note that the first white settlers of the Bitter Root Valley suffered from what was considered a very fatal form of “black measles.”
In 1902 Wilson and Chowning reported that the disease was due to a piroplasm of the squirrel and that it was transmitted to man by the bite of a tick (Dermacentor venustus). Later Ashburn and others, while accepting the tick transmission, failed to corroborate the piroplasm etiology.
It is chiefly to Ricketts that we owe much of our detailed knowledge of the epidemiology of the disease.
The work of McClintic and Frick along lines of prophylaxis has given us practical measures for the control of the disease.
The views of Ricketts, Wolbach and Frick as to etiology are discussed under that heading.
Geographical Distribution.—The two best known regions of prevalence of the disease are the Bitter Root Valley of Montana and the Snake River Valley of Idaho.[447] It is also reported from limited sections of Washington, Oregon and California, as also from Nevada and Utah.
In Wyoming it is rather widely distributed.
Etiology and Epidemiology
Etiology.—Wolbach states that he has noted certain bacterial forms in the endothelial cells of the blood vessels of guinea pigs infected with the virus, as well as a very general distribution in infected ticks.
There are two morphological types—one, a chromatic-staining lanceolate diplococcoid organism, found in the circulating blood as well as in the endothelial cells, the other type—a blue-staining rod-shaped form.
Ricketts noted certain chromatin-staining bacteria, in man and in eggs of infected ticks, which were about 1 micron long by ⅓ micron broad, showed chromatin staining, were about the size of B. influenzae, and appeared as two lanceolate-shaped bodies. These bodies are now considered as belonging to the Rickettsia group of organisms. Wolbach has named the organism of spotted fever of the Rocky Mountains Dermacentroxenus rickettsi. In infected guinea pigs Wolbach found these bodies particularly abundant in the endothelial cells.
Frick has also found bodies within the red cells of human cases and infected guinea pigs, as well as extracellularly, which showed chromatin-staining characteristics, there often being an elongated reddish body joined on to a larger blue-staining protoplasm.
In 1902 Wilson and Chowning reported the finding of piroplasm-like bodies in the blood of human cases of Rocky Mountain Spotted Fever. Ricketts proved that the virus was not filterable. A tick, Dermacentor andersoni transmits the disease.
Epidemiology.—The transmitting tick, D. andersoni (D. venustus) lives on the domesticated animals of the region of geographical distribution of the disease. Ricketts showed that the reservoir of the virus was to be found in ground squirrels, chipmunks, mountain rats, etc., and that ticks feeding on these rodents become infected and transmit the disease to man. The guinea pig, white rat and monkey are also susceptible.
The virus can be propagated indefinitely in guinea pigs without loss of virulence by weekly blood inoculations in another animal. The virus seems to be transmitted by the salivary secretion of the tick and a tick once infected remains infective for the remainder of life.
Frick succeeded in obtaining anaerobic cultures from infected blood of a bacillus, somewhat resembling the B. typhi exanthematici of Plotz. These bacteria, however, did not show complement fixation with immune serum and were nonpathogenic to guinea pigs.
Spotted fever is a disease of rural districts and tends to give only one case to a house, thus indicating the negative rôle of bedbugs, lice, etc. It is at the time when[448] ticks are most abundant, in the months of the spring, that the disease makes its appearance. The virus is in the blood during the entire febrile course.
Pathology
The cadaver shows marked jaundice with petechial spots on extremities and trunk.
There is marked venous engorgement and the blood is very dark and fluid.
In the blood vessels we have proliferation of the endothelial cells leading to thrombosis.
Ricketts noted enlargement of the lymph glands. The spleen is three or four times the normal size and is quite firm. Microscopically it shows extensive endothelial cell proliferation. The kidneys are enlarged and congested. Gangrene of the prepuce and scrotum are often noted.
Symptomatology
The period of incubation is from five to ten days when the disease sets in with considerable abruptness, with more or less marked rigors, headache, malaise and severe pains of the larger joints, but without inflammatory changes.
Some cases present a prodromal period lasting a day or so with malaise and chilly sensations followed by the symptoms noted above. Hyperaesthesia and photophobia are apt to be present during the course of the disease.
The eruption first appears from the second to the fifth day as macules about the wrists and ankles, thence spreading over the extremities and extending to the trunk. These macules tend to become petechial.
The Pulse.—The pulse is not very rapid (90-110) and the fever steadily rises day by day from the initial 102°F to reach a maximum of about 105°F. by the end of a week or so. A toxaemic condition appears early.
A stuporous state is fairly common but in many cases the mind is clear throughout the course.
The spleen is palpable early in the disease and is quite firm, not soft like the spleen of typhoid fever.
The kidney involvement shows itself early as an albuminuria.
Constipation is rather a constant feature.
Icterus and vomiting tend to come on later in severe cases.
Gangrene.—Gangrene of the tonsils, scrotum and prepuce are more common in the milder type of the disease, as seen in Idaho, than in the more severe one of Montana.
There is leucocytosis early in the disease, falling to about 10,000 after a few days. There is an increase in the large mononuclears. The eosinophiles are decreased in percentage.
Diagnosis
The association of a tick bite and proper geographical distribution is of prime importance. The more sudden onset, joint pains and negative Widal differentiate it from typhoid fever.
Typhus fever shows more marked abruptness of onset and decline of fever than does Rocky Mountain fever. The guinea pig, while susceptible to both infections, is more easily infected with this disease than with typhus fever.
As a matter of fact there are marked clinical resemblances between typhus fever and Rocky Mountain fever. Tsutsugamushi and trench fever also have points of resemblance.

Prognosis
It is very remarkable that the disease should rather constantly give a mortality approximating 75 to 90% in western Montana and only about 5% for Idaho.
Where the nervous manifestations are marked the prognosis is more unfavorable. Death tends to occur in the second week and patients living through this week have a good chance for recovery. The death rate is greatest in old people and least in young children.
Prophylaxis and Treatment
Prophylaxis.—Dermacentor andersoni requires a long time to become attached and feed on the human host—at least one or more hours—hence inspection of one’s person for ticks after returning from exposure and removing those found would tend to prevent infection.
When these ticks attach themselves to the wool of grazing sheep, 87% seem to die, possibly from the effect of the fat in the wool.
Again such sheep can be dipped for further destruction of the ticks.

Treatment.—Just as with typhus fever the most important point in the care of the patient is good nursing. The room should be darkened and quiet maintained. Cool sponging lowers the temperature and is a tonic for the nervous disorders. An ice cap is good for the headache. The diet should be liquid and water should be given freely on account of the tendency to renal involvement.
There is a tendency to heart failure so that the recumbent position is demanded and cardiac stimulants indicated.
Michie and Parsons found sodium citrate of greatest benefit in treating infected guinea pigs and recommended it for human cases. It is to be used intravenously and about 60 cc. of a 5% solution given twice daily. Immune sera were tried out by Ricketts, but without result.
CHAPTER XXXIX
TYPHUS FEVER
Definition and Synonyms
Definition.—Typhus fever is an acute infectious disease, possibly caused by Rickettsia prowazeki. There is a fairly abrupt onset, with a continued fever lasting about two weeks, followed by a critical fall or rather rapid lysis of temperature. About the fifth day a rose spot eruption, similar to that of typhoid, first appears about the loins and abdomen later on extending over the trunk and extremities. The rash tends to become petechial and stands out rather prominently on a general cutaneous mottling. The stuporous state is a marked feature of the disease. It is transmitted by lice.
Synonyms.—Jail fever; Ship fever; Putrid fever; Petechial fever; Typhus exanthematicus. Ger. Fleckfieber; Fr. Typhus exanthématique; Sp. El tabardillo; Ital. Typho-esantematico.
History and Geographical Distribution
History.—Hirsch notes that the history of typhus fever belongs to the dark pages of the world’s story, at times when war, famine, and misery of every kind are present. It is reasonable to suppose, according to this author, that many of the pestilences of ancient times and the Middle Ages were typhus fever. This disease was prevalent among the Spanish soldiers at the time of the conquest of Grenada and the designation of the disease then used (Tabardillo) is the one now given typhus fever in Mexico.
The disease was first described with sufficient accuracy by Frascatorius, in the 16th century, to enable us distinctly to differentiate it from plague; the stuporous states of the two diseases having previously caused them to be confounded. In England, in the 16th century, the disease was very prevalent in the jails and court officials attending the trials of prisoners often contracted the disease and died; hence the designation “black assizes.”
During the Thirty Years War, in the 17th century, typhus fever spread over central Europe.
Typhus fever was very prevalent at the time of the epidemic of plague known as the great plague of London and it is a matter of practical interest that the two diseases were not infrequently confounded by medical men. There were some very severe epidemics of the disease in Ireland in the 19th century.
Typhoid fever and typhus fever were only separated as distinct diseases by Gerhard, 1837. Huxham, however, had previously noted the marked difference between putrid malignant fever and slow nervous fever.
Until very recent times it was declared that typhus fever was among the most contagious diseases of man and innumerable instances were cited of frequent contagion of those attending or visiting typhus patients. In 1909, Nicolle, in North Africa, demonstrated that the disease was transmitted by lice and the recent experiences in the Balkan war and in the Servian epidemic of 1915 show that in the absence of such vermin the disease does not appear to be contagious.
Geographical Distribution.—The disease has largely been eradicated from European and other countries where hygienic measures leading to the destruction of vermin have existed.
During the recent war the disease became one of importance, owing to the difficulty of preventing the spread of body lice to the soldiers.
In the tropics the disease, when present, is usually found in regions of high altitude. In Mexico tabardillo, as typhus is there designated, is a disease of the elevated regions. This is also true of India.
Sporadic cases of typhus, known as Brill’s disease, have appeared from time to time in New York.
During the great war typhus first appeared in Servia, thence extending to Austria, Germany and Russia. Its nonappearance on the Western battle line must be attributed to the active measures of the Germans in attacking the lice problem. It is now widespread in Russia and Poland.
Etiology and Epidemiology
Etiology.—Recent work by Anderson and Ricketts has shown that the blood of human cases is infective for monkeys. The virus does not seem to pass through a Berkefeld filter and the epidemiology points to the body louse as the sole transmitting agent. Nicolle reported the filterability of the virus. More recently he has considered this filterability as doubtful.
The guinea pig is susceptible to the virus as well as the monkey but only shows temperature rise. Nicolle has shown that lice do not become infective until about the tenth day after feeding on typhus blood. The virus is found in the blood of man and in the spleen and blood of monkeys and guinea pigs.
Plotz has isolated a Gram-positive pleomorphic bacillus from the blood of typhus patients which has been named B. typhi exanthematici. This organism is of historical interest only and apparently has nothing to do with the causation of typhus fever.
Hort states that only blood recently taken from typhus patients will cause the disease in monkeys while the same blood which has been incubated several hours or days fails to produce the disease. Others, as well as Hort, doubt the etiological relation of the organism of Plotz to typhus fever or to the mild form of the disease as seen in New York City and there known as Brill’s disease. Tabardillo or Mexican typhus is the same as typhus.
Rocha-Lima insists upon the etiological importance of short oval bodies, often showing polar staining with Giemsa preparations, and found in the epithelial cells of the alimentary tract of lice which have fed on the blood of typhus patients.
Ricketts noted similar bodies in such lice. They differ from the Plotz organism in that they are Gram-negative and apparently cannot be cultivated. Lice feeding on blood other than that of typhus patients fail to show these bodies and furthermore the blood of typhus cases during the period of convalescence fails to infect lice. When guinea pigs are inoculated with emulsions of lice containing such bodies they show the temperature reaction of typhus fever. Plotz states that his organism may be Gram-negative at first and believes these organisms to be the same. Wolbach and Todd take the view that the bodies described by Rocha-Lima and called Rickettsia prowazeki are the cause of typhus fever. Similar bodies have been found in trench fever and even in certain normal lice. These bodies, however, are extracellular and are more oval and stain more intensely than the typhus bodies. These Rocha-Lima bodies require a Romanowsky stain to bring them out. In man these bodies are found in the endothelial cells of the small blood vessels, occurring singly or in clumps. In the louse the epithelial cells of the intestine may be found distended with masses of these organisms.
It is not certain whether the virus is transmitted by the bite of the louse or by inoculation of faeces. Monkeys and guinea pigs can be infected by injection of emulsions made from infected lice.
Loewe and others have succeeded in cultivating the virus of typhus, using deep tubes containing 10 cc. of a rich ascitic fluid and a piece of sterile rabbit kidney. The medium was inoculated with 2 cc. of typhus blood, after which 0.3 cc. of a 20% dextrose solution was added and the culture sealed with liquid petrolatum. Its reaction was pH 7 to 7.4. Cultures were incubated at both room and body temperature.
As proving the culturing of the virus, it was noted that 1 cc. of a fourth-generation culture would infect a guinea pig. This would represent 0.00000016 cc. of the original typhus blood. The bodies cultivated differ in morphology from the bacillus of Plotz in that they are even more minute, of slight hazy outline and do not assume polymorphous involution forms. They vary also in cultural characteristics. Concerning the question as to the identity of the bodies with Rickettsia prowazeki, no definite decision is as yet permissible, nor were the authors able to decide whether the bodies are of bacterial or of protozoan nature.
Epidemiology.—Until recently authorities stated that typhus fever was the most contagious of all diseases. We now know that in the absence of body or possibly head lice the disease is only slightly, if at all contagious.
At the same time recent experience has shown that it requires the greatest care on the part of those having charge of louse destruction to avoid being infected while attending to this duty. The same is true of those examining patients with the disease prior to the eradication of the body lice of the sick.
A knowledge of the life history of the body louse is necessary. The body louse, Pediculus vestimenti, is slightly larger than the head louse, P. capitis, and is the species concerned in the transmission of Indian and North African relapsing fevers as well as typhus fever, although it is probable that the head louse can also transmit these infections.
While the head lice live among the hairs of the head and show their presence chiefly by the appearance of their pear-shaped eggs (nits) projecting from the hair shaft, the body lice attach themselves to the under surface of the garments worn next the skin, and holding fast to the undershirt, feed about twice daily on the human host. They are but rarely found on the skin. The female body louse is about ⅐ inch long and about 1/15 inch broad (3.5 mm. × 1.5 mm.). The antennae are somewhat longer than those of the head louse. Warburton found that the egg stage, in experiments, lasted from eight to forty days, the larval stage about eleven days, and that the male louse lived three weeks and the female four weeks. Of course, under natural conditions these periods may not hold. Development of the eggs takes place best at a temperature of 30°C.
Lice feed at once after being hatched and a young louse will die unless it feeds within 24 hours.
Lice will leave their host only when he has fever or when he dies but they may drop off a host or be brushed off. They are not apt to be found in bedding.
Pathology
Fraenkel, in 1914, first called attention to proliferative changes in the endothelium of the arterioles and arterial capillaries, followed by necrotic changes. These changes are chiefly manifest in the vessels of the skin, central nervous system and myocardium. In addition to the proliferation of the endothelial cells we have a perivascular infiltration of small round cells. Kurt Nicol notes that there is a combination of proliferative and inflammatory changes. These are microscopical and there is absence of characteristic macroscopic findings.
The petechiae are due to thrombosis of the smaller vessels and subsequent haemorrhagic manifestations. Bronchitis and broncho-pneumonia are extremely frequent and form the most common fatal complication. The brain lesions are most common in the basal ganglia, the cerebral cortex and the medulla.
The blood is dark-colored and the liver and kidneys show cloudy swelling. The spleen is somewhat enlarged during the early stages of the disease but tends to be normal in size later on. It is very soft and may rupture while being handled at autopsy. There are no changes in the Peyer’s patches and the mesenteric glands are not enlarged, thus[455] differentiating from typhoid fever. The heart muscle tends to show degenerative changes.
Symptomatology
The period of incubation varies from five to fifteen days, usually, however, about twelve days. The period of onset may cover about two days, during which time the patient has headache, giddiness, backache, anorexia, perhaps nausea, and general malaise. There may be rigors or chilly sensations.

About the end of the second day the temperature rises fairly rapidly to become 103° or 104°F. by the third or fourth day. With the rise of fever the face becomes flushed, the eyes injected and the expression apathetic. The headache is usually quite severe and may be frontal, occipital or generalized. The temperature remains elevated with slight morning remissions for from twelve to fourteen days when it may fall by crisis or more gradually by rapid lysis.
Well-marked prostration and cardiac weakness are early noted. There is a tendency to constipation and the mouth becomes foul and the teeth rapidly covered with sordes, unless the greatest precautions in oral cleanliness are observed.
There is a marked tendency to clouding of the consciousness. At times the disease shows an abrupt onset rather than that described above.
The eruption first appears about the fifth day and shows as slightly elevated rose spots, which at first disappear on pressure, but quickly tend to become permanent and later purpuric. The eruption first appears in the flanks and then extends to the abdomen, chest and later to the extremities.
The term mulberry rash is sometimes used to describe the rash of typhus. In addition to the above there is a subcuticular mottling.
Along with the appearance of the rash the symptoms become aggravated, the effect on the heart is more marked and the pulse becomes feeble. The face is often dusky. There may be a bronchial catarrh with an annoying cough.
By the end of the first week the delirious or stuporous condition becomes more marked with a tendency to muttering delirium, tremors and subsultus, the coma-vigil of the older writers. Terrifying hallucinations may cause the patient to jump from the window and kill himself. There is a tendency to parotitis and otitis[456] media connected with the mouth condition. On account of the circulatory weakness there is a tendency to gangrene of the extremities, especially the toes, rarely the fingers.

In cases which recover there is a critical change in the apparently desperate condition of the patient about the end of the second week, the sudden striking change for the better being more marked in typhus fever than in any other disease. At this time the urine changes from a high-colored, often albuminous one, to an abundant secretion of more or less normal character.
The sporadic mild cases of typhus, which occurred from time to time over a period of years in New York, were known as Brill’s disease. According to Brill these cases showed intense headache, apathy and prostration, with a continuous fever, maculo-papular eruption and a rapid lysis or critical fall of temperature at the end of about fourteen days. The spots only rarely became purpuric. There was almost never marked delirium and the mortality was less than 2%.
Symptoms in Detail
The Eruption.—This first appears about the fourth day as macules about loins, then spreading over abdomen, chest and back. It is often more pronounced on the back than elsewhere. It almost never appears on the face but may occur on the[457] palms and soles. It has a resemblance to the rash of measles. At first disappearing on pressure it soon becomes permanent and then petechial. The livid color of the rash has brought about the designation “mulberry rash.” The rash lasts from a few days to two weeks.
The Fever.—The fever rise following a chill is much more rapid than in typhoid fever, reaching its fastigium in about three days. A more or less continuous range of fever (103° to 104°F.) follows until about the fourteenth day, when there is often a rapid lysis or possibly crisis, at which time the patient tends to fall into a refreshing sleep and to show a rather marked diuresis.
The Alimentary Tract.—Constipation is usually noted. Very marked is the tendency of the mouth and tongue to become dry and sordes to collect on the teeth. The dry black tongue has led to the designation “parrot tongue.” It is difficult to get the patient to protrude his tongue when told to do so.
The Circulatory System.—Very outspoken is cardiac weakness due to myocardial degeneration. The heart sounds are very weak and the pulse feeble. The blood pressure is very low, especially the diastolic. Bradycardia may be marked during convalescence.
The Respiratory System.—Cough may appear in the first days, but usually is first troublesome about the time of the eruption. By the end of a week the cough becomes loose and râles of various types may be noted. Death often occurs from a terminal broncho-pneumonia.
The Nervous System.—Clouding of the consciousness is as marked in this disease as in plague. Dull aching frontal headache is marked and a dull stuporous state soon comes on. Delirium is marked in some cases. As in plague there are often the facies and mental state of alcoholic intoxication.
The Blood.—There does not seem to be anything very characteristic in the blood examination. Prowazek noted that the polymorphonuclears showed early fragmentation of the nucleus and that the cytoplasm stained very red with Giemsa’s stain. Robinowitsch noted that the leucocyte count fell in the first day or two, then gradually rose until the crisis and then again fell. The leucocytosis is only moderate, about 10,000, and the polymorphonuclears make up about 80 to 85%. Eosinophiles are decreased. Other observers have noted an increase in the large mononuclears.
Complications.—A bronchitis is very common and later on there may be such a profuse expectoration that the patient cannot get rid of it and may become cyanotic. Broncho-pneumonia is a very frequent cause of death. Otitis media and parotitis are not infrequent complications. Deafness is often marked.
Thrombosis of various vessels may be noted.
Gangrene of the extremities, especially the toes, is frequently present. Gangrene of areas subjected to pressure, as over the sacrum, is not infrequent. There does not seem to be the same tendency to gangrene of the genitalia as in spotted fever of the Rocky Mountains.
Diagnosis
The more gradual course of the fever and the less marked stuporous condition, together with positive blood cultures, should differentiate typhoid fever.
Plague has the same picture of alcoholic intoxication as typhus, but is without the rash. Influenza, with its acute onset, is confusing but does not show any increase in leucocytes.
Other than a moderate leucocytosis and marked acid staining of the polymorphonuclears there is not much that is of help from the laboratory. When guinea pigs are inoculated with typhus virus the period of incubation is from 7 to 10 days.
Weil-Felix Reaction.—In the diagnosis of typhus fever we attach great importance to an agglutination reaction (Weil-Felix reaction) which the serum of typhus patients has upon certain organisms designated as X2 and X19. These correspond in characteristics to certain strains of Proteus vulgaris, producing indol in peptone solution, and acid and gas in glucose, maltose and saccharose, but not in lactose or mannite. They digest gelatine and blood serum somewhat more slowly than typical cultures of Proteus vulgaris.
Although these organisms have been isolated from the urine of several typhus cases, it seems certain that these X bacilli are neither causative organisms nor secondary invaders. The reaction is therefore heterologous and not specific.
The reaction appears during the first week of the disease but becomes quite marked in the second week and during convalescence. Thus a titre of 1 to 25 on the fifth day usually rises to 1 to 200 or higher by the end of the second week. The test is made either with living or dead cultures and is carried out as for typhoid agglutinations, preferably by the macroscopic method.
Prognosis
Old people are apt to succumb, as do also those who show marked delirium. In childhood it is a very mild disease.
An increase of eosinophiles is favorable while an absence of these cells makes for a grave prognosis.
The death rate runs from 15 to 60% in many epidemics while Brill’s disease only gives 1 or 2% of deaths.
Prophylaxis and Treatment
Prophylaxis.—This consists almost exclusively in the destruction of body lice, or preventing their access to the person.
Those attending cases should wear gowns, closely fitting at neck and wrists, and rubber gloves. Better than a gown would be “unionalls,” with stocking extremities[459] to go over the shoes. The typhus case should be deloused with the greatest thoroughness, and his clothing sterilized.
For ridding the body of lice, the following steps are essential:
1. The hair of the body and head should be clipped.
2. The subject should be bathed, there being used freely kerosene-emulsion soap, prepared by boiling 1 part of soap in 4 parts of water, and then adding 2 parts of kerosene oil. The resultant jelly, when mixed with 4 parts of water, makes a liquid soap that is convenient to use and which may be applied effectively.
3. Following the bath, the body may be anointed with kerosene, special care being devoted to the hairy parts. Skin irritation may, however, require early removal of the oil.
4. It has been found that lice on clothing removed from the body may remain alive nine days and their eggs as long as forty days. The clothing therefore should be disinfected by one of the following methods:
(a) Steam; (b) boiling for five minutes; (c) 5% compound cresol solution for 30 minutes; (d) chemicals such as cyanide or chlorpicrin.
5. In the absence of facilities for carrying out the steps described, or to prevent infestation subsequently, dusting powders are sometimes used. Of these the N.C.I. powder, containing commercial naphthalene, 96 Gms., creosote, 2 cc., and iodoform, 2 Gms., is the most widely known; but Moore’s powder—creosote, 1 cc.; sulphur, 0.5 Gm., and talc, 20 Gms.—is less irritating and is said to be six times as effective. It has also been recommended to wring out the underclothes in 5% compound cresol solution, then drying thoroughly, or to impregnate them with substances such as the halogenated phenols.
Treatment.—There is no disease in which careful nursing is so important. This applies especially to the care of the mouth. It is very necessary to maintain the recumbent position.
A mouth wash of equal parts of boric acid solution, glycerine and lemon juice should be used to swab out the mouth several times daily. Constipation should be controlled by enemata.
It is best to give the patient abundance of fresh air so that tent treatment is to be recommended. Cool sponging lessens the nervous manifestations as well as lowering temperature. Ice bags to the head relieve the headache. Cardiac stimulants are indicated, as caffein and camphor. Thyroid extract has been recommended. Lumbar puncture has given amelioration of symptoms. Abundance of water should be given and the diet should be milk and broths.
The virus of typhus is present in all the organs of an infected guinea pig and Nicolle has prepared a serum by injecting horses with emulsions of spleen and adrenals of such animals. The serum has apparently given good results in human beings when employed early in the disease, the temperature falling with each injection. The dosage was about 20 cc. daily.
CHAPTER XL
TRENCH FEVER
Definition and Synonyms
Definition.—Trench fever is a specific, acute infectious disease, probably caused by Rickettsia quintana, acquired usually through the agency of the body louse, characterized by an abrupt onset, a febrile period of about five days often followed by one or more relapses, and ending in complete recovery.
Trench fever was one of the most widespread diseases occurring in the forces of the World War. It is transmitted by contamination of a skin abrasion or of a louse-bite wound with the faeces of an infected louse, although Strong and his colleagues reported the bite of an infected louse as a demonstrated method of infection.
Clinically, it shows an abrupt onset, with fever, headache, pain on moving the eyeballs, soreness of the muscles of the legs and frequently hyperaesthesia of the shins. As a rule the initial fever is followed after a few days by a single short rise but there may be a fever course of many relapses with apyretic intervals. Recovery is complete, death practically never occurring; but convalescence may be protracted, and incapacitating after-effects, such as neurasthenia, cardiac disturbances and myalgia, may be noted.
Synonyms.—Pyrexia of Unknown Origin (P. U. O.), Meuse fever, Volhynian fever, Shin fever, Quintan or five-day fever.
History and Geographical Distribution
History.—It is remarkable that so striking and communicable a disease as trench fever should have been an unrecognized entity prior to the recent war. While resembling dengue in some respects, and relapsing fever in others, as well as various well-recognized exotic fevers, there is no satisfactory account of the prior existence of such a type of fever. Werner was of the opinion that a quintan fever of the Middle Ages might have been trench fever, and it has been suggested that a quintan fever described by Hippocrates may have been of this nature, but the evidence is not convincing. Some have thought that the miliary fever reported in France from 1821 to 1855 might have been a type of trench fever since it had no mortality.
Geographical Distribution.—During the war, trench fever was reported not only in Flanders, but also among the troops fighting in Macedonia and Mesopotamia, and in the forces of the Central Powers on the German and Austrian fronts. It is remarkable that since the war this louse-borne disease seems to have disappeared, although other diseases transmitted by lice, as typhus fever and relapsing fever, continue to occur widely in Poland, Russia and the Balkans.
Etiology and Epidemiology
Etiology.—It now seems rather definitely settled that trench fever belongs to the group of diseases caused by Rickettsia bodies, and this species has been named Rickettsia quintana. Like the other organisms of the group, these bodies are very small (0.3 to 0.5 by 1.5 to 2 microns), Gram-negative, nonmotile and stain best by Giemsa’s method. As these bodies with their coccal or bipolar staining characteristics, when observed in the eggs of ticks infected with the virus of spotted fever of the Rocky Mountains, showed the so-called chromatin staining, Ricketts regarded them as chromatin-staining bacteria. Since, however, they are transmitted by an arthropodan host, we believe now that they are probably protozoal in nature.
Bradford and his colleagues stated that they were able to culture these organisms by Noguchi’s method for culturing the organism of syphilis, but Strong failed to obtain growth. As the organism of typhus fever has recently been cultured by the same method, it would appear that the trench fever organism also is cultivable. The virus is present in the whole blood, in the plasma and in the washed erythrocytes; it is nonfilterable, and withstands a temperature of 56°C. for 20 minutes but not one of 80°C. for 10 minutes. These organisms in the alimentary tract of the louse are extracellular, and not contained within the cells of the epithelium of the gut of the louse. The trench fever bodies differ from those of typhus in that they are plumper and stain more deeply with ordinary aniline dyes.
Epidemiology.—The ordinary method of transmission is by the agency of infected lice, but the disease can be produced artificially by the injection of the blood of an infected person. It is probable that urine also may be a factor in transmission, as Strong brought about infection by smearing skin abrasions with urinary sediment from trench fever cases.
It is now considered that the bite of the louse is noninfectious, although Strong succeeded in transmitting the disease by this means in five cases. The accepted explanation of the mechanism of infection is that it takes place through contamination of an abrasion or wound of the skin with louse faeces or with the juices from the crushed bodies of infected lice. In this connection, excoriations of the skin resulting from the scratching of scabies-infested areas makes a scabies patient[462] peculiarly liable to trench fever infection. The louse faeces become infective only after seven days from the time of feeding on trench fever cases, this fact indicating a developmental cycle in the louse.
Pathology
As the disease of itself is never fatal, there have been no opportunities for studying the pathological changes.
Symptomatology
The period of incubation is usually given as from two to three weeks. In the experimentally produced cases of the American Red Cross Commission, the incubation period varied from five to thirty days; thus with intravenous injection of blood it varied from five to twenty days, and with inoculation of scarified areas with louse faeces the period was between seven and eleven days.
The onset is quite abrupt with headache, dizziness and pain on motion of the eyeballs. There is pain also in the back and limbs. The conjunctivae are injected. The fever rises rapidly to 102°-104°F. and falls rather abruptly to normal at about the fourth day. In most of the cases a secondary rise occurs so that we may have a saddle-back type of temperature chart.
The temperature charts tend to be grouped in three classes: (1) Those with a short febrile course of a few days, followed by a fall to normal, with or without a subsequent rise; (2) those with a more or less sustained type of fever, extending over five or six weeks without distinct relapses, and (3) those more typically of a relapsing type, with five or six distinct febrile periods.
In more than one-half of the cases there occurs an eruption of small (2 to 4 mm.) erythematous spots, which disappear on pressure. They are usually located on chest, back or abdomen, appear on the second day of the fever, and fade out by the fourth day. Constipation and anorexia are usually noted. The spleen is often somewhat enlarged. There is frequently a trace of albumin in the urine, but it is not accompanied by casts. The cutaneous hyperaesthesia over the shins is a prominent feature, but the same disturbance of sensation may be complained of over the ulna or fibula. Usually we find a leucocytosis but many cases show a normal white count or even a slight leukopenia. During the apyrexia there is an increase in mononuclear percentage. The pulse is rather slow for the temperature.
Diagnosis
Notwithstanding the intensive study given this disease during the war, we do not seem to have any constant or reliable laboratory test.
In some of the cases where muscle pains of the neck are marked[463] there may be a stiffness of the neck that is suggestive of cerebro-spinal fever. Similarly, pain of the abdominal muscles may cause a suspicion of appendicitis and lead to an unnecessary operation.
The onset of trench fever is very like that of dengue or influenza.
In epidemic jaundice, the occurrence of the jaundice and marked albuminuria should differentiate.
Prognosis
This is most favorable as to ultimate complete recovery, but some cases show a prolonged convalescence with manifestations of irritable heart or neurasthenia.
Prophylaxis and Treatment
Prophylaxis consists in attacking the louse problem, although attention should be given to the disinfection of the urine.
Acetylsalicylic acid may be given to relieve the headache and the muscle pains; and some laxative for the usual constipation. There is no specific treatment.
CHAPTER XLI
HEAT STROKE AND HEAT PROSTRATION
General Considerations
It has been customary to differentiate etiologically, as well as clinically, the two most common manifestations of the effects of high temperature. Clinically we note cases (1) with a rapidly rising temperature, which often reaches a very high point, together with a hot, dry, reddened skin, heat stroke; and again we note cases (2) with pale clammy skin, marked evidences of cardiac weakness and a normal or subnormal temperature, heat prostration.
Brooks in a most excellent discussion of the subject applies the designation diathermasia to the former group of cases and regards them as connected with an undue retention of heat within the body. To the latter group, which he considers to be connected with exposure to the actinic rays of the sun, he applies the designation phoebism.
In diathermasia he considers that we have so great a strain on the thermotaxic mechanism that there is loss of balance between the heat discharge and heat producing centers, while in phoebism there is primarily an acute cerebral or cerebro-spinal congestion followed by a chronic inflammatory condition of the meninges and due to damage from the actinic or ultra-violet rays of the sun.
While admitting that there may be cases where the effects of certain rays of the sun are responsible for clinical manifestations varying from death of striking suddenness to vague complaints of irritability, headache and defective memory, yet the generally accepted views are that high temperature, high relative humidity and lack of evaporation from the skin, whether from excessive humidity or from lack of circulation of the surrounding air, can and do produce at one time heat stroke and at another heat prostration. Such factors as muscular exertion, disease conditions, alcoholism and dietary indiscretions undoubtedly play a part in the production of and variance in the clinical manifestations brought about by the effects of heat.
Sambon has suggested that there is a possibility that heat stroke or, as it is also designated thermic fever or siriasis, is due to a germ infection, but without advancing any particular evidence in favor of such an hypothesis.
There is undoubtedly, however, much in favor of the views of those who regard heat stroke and heat prostration as due to an auto-intoxication from the accumulation of toxic substances resulting from increased metabolic activity due to excessive heat retention and having a selective action on the nerve cells.
Others think that as the result of more active metabolism there is a retention of carbonic and lactic acid with a demand on the alkali content of the blood resulting in an acidosis. As a matter of fact treatment of heat stroke cases with intravenous or rectal injections of sodium bicarbonate seems to be of marked value.
It would seem advisable to take the ground that heat retention resulting from lack of heat radiation and insufficient skin evaporation causes various manifestations of discomfort or bodily injury. Aron in Manila showed that monkeys exposed to the sun died in about one hour but that a control monkey, similarly placed, but kept in a current of air from an electric fan, suffered little or no injury. The reason that monkey and man react differently to exposure to the sun is on account of the more numerous and more active sweat glands possessed by man which give rise to increased evaporation and resulting loss of heat of the body.
High relative humidity is a potent factor in checking evaporation. The rectal temperature in Haldane’s experiments showed a rise of a little over 1°F. when the wet bulb was at 90°F., 2°F. when at 94°F. while at 98°F. it was about 4°F. per hour. Leonard Hill has noted that the air surrounding the victims of the Black Hole of Calcutta became saturated with water vapour and heated to the temperature of the body so that it was heat stroke and not suffocation that caused death. The power of air to hold water vapour and its evaporative power increase rapidly with rising temperature; thus at 50°F. a cubic foot of air holds 4.08 grains water, at 80°F. 10.9 and at 100°F. 19.7 grains. Hill states that the limit of an Englishman’s power to keep cool is passed when the wet bulb exceeds 88°F. in the still air of a room even when stripped to the waist and resting. If muscular work is performed the limit may be 80°F. Walking in a tropical climate, wet bulb 75° to 80°F., dry bulb 80° to 90°F. may raise the temperature 2° to 3°F. and send the pulse up to 140 to 160. All the students of ventilation stress the importance of circulation of the air in promoting evaporation and comfort. According to Hill with the air saturated and the wet bulb reading 89°F. the wet ‘Kata’ readings would be 3.3 with still air, 8.0 with the wind moving 1 meter a second and 15.1 with a velocity of 9 meters per second. In tropical parts of the world when the wet bulb not infrequently reaches 90°F. the circulation of air by punkahs or electric fans becomes a necessity. There is great variation in capacity for sweating which, according to Hearne, is the basis of heat stroke. He notes that sweating is suppressed from 1 to 48 hours before the attack. With sweating suppressed the body temperature rises until, when 108°F. or more is reached, unconsciousness and convulsions develop. Hearne thinks that[466] the inhibition of sweating is local in the sweat glands, and not central, as diaphoretics fail to cause sweating once it has stopped. As a practical point Hearne watched subjects for dryness of the skin and when discovered they were stripped, covered with a wet sheet and evaporation promoted by a current of air from an electric fan. Doctor Leonard Hill has noted the inefficiency of the application of pieces of ice to the hyperpyrexial body as compared with evaporation. Thus water evaporation at body temperature abstracts 0.59 calories per gram while melting ice only takes away 0.08 calories. Furthermore the application of ice constricts the capillaries and interferes with evaporation. He also notes that 70 grams of water evaporated from the skin takes away as much heat as 1000 grams of ice water used as an enema.
Pathology
Pathologically, there is usually congestion of the brain and meninges, that of the brain being particularly marked about the region of the medulla. There may even be punctate haemorrhages and the nerve cells show chromatolysis. These changes are much more evident in heat stroke than in heat prostration.
McKenzie and LeCount have noted the following autopsy findings: Generalized passive hyperaemia of brain and lungs, oedema of brain and lungs as well as petechial haemorrhages of various mucous membranes and the skin.
Susceptibility to Heat Stroke.—As a matter of fact in a body of men exposed to identical conditions of heat of sun and relative humidity we note certain cases exhibiting typical heat stroke while other men will only show evidences of heat prostration.
Alcoholism, obesity, diseases of heart and lungs, overcrowding, muscular fatigue, insufficient circulation of air, with the wet bulb about 90°F., and not drinking a sufficient amount of water, predispose to heat injury.
It must always be kept in mind that the hyperpyrexial type of malignant tertian malaria may give a clinical picture of heat stroke.
Fiske has noted that in oil-burning firerooms, even with a temperature of 140°F., 10° higher than on similar ships burning coal, there were no cases of heat prostration. He attributes this to the less fatiguing work in tending oil-burning furnaces and the smaller number of men required, this reducing overcrowding.
Symptomatology
In heat stroke there are usually prodromata of dizziness, dry skin, headache, and somnolence, following which the body temperature shoots up to 105°F. or even above 110°F. There is a desire for frequent micturition, which may be considered as a prodromal warning of embarrassment of the sweating function. The skin is hot and dry and the pupils may be contracted. The pulse which is at first full and rapid, soon becomes irregular. There may be delirium or coma or convulsive seizures. The patient is unconscious with irregular or Cheyne-Stokes respiration.
Hiller divides these cases into (1) those showing an asphyxia syndrome, as characterized by cyanosis and collapse, with cessation of respiration and enfeebled circulation. Prolonged artificial respiration is required in such cases. (2) A paralytic type with deep coma, recurring convulsions and extreme hyperpyrexia. These cases exhibit oedema of lungs and brain and necessitate venesection. (3) A psychopathic type in which there is delirium often of a violent type with delusions of persecution. Such cases often commit suicide.
In heat prostration we have giddiness and possibly nausea with pale face, often bathed in cold perspiration and dilated pupils. The pulse is very weak and syncope may ensue. The temperature is not elevated and may be subnormal. Rarely the temperature is slightly elevated. The respiration is shallow and sighing. Headache is often complained of after recovery. Following this or the more dangerous heat stroke we may have lack of mental concentration or loss of memory with recurring headache upon even moderate exposure to the sun.
Heat Cramps.—Among those working in firerooms on board ships cruising in tropical waters, there is met frequently a condition characterized by cramps of the voluntary muscles, chiefly those of the extremities and abdomen.
Ill health and individual susceptibility appear to predispose toward attacks, but apparently hard physical labor, in conjunction with the environmental conditions, is the factor that determines the occurrence of the cramps. Their causation is usually attributed to dehydration of the tissues, or to accumulation of metabolic products, but some believe that they represent a condition differing from all other conditions recognized as being due to heat. Cases, probably identical in nature and having the same causative factors, have been noted as occurring among workers in steel-mills.
The cramps are usually preceded by fibrillation of the muscles later to be affected. When frankly spastic attacks are developed, they recur at intervals of from 2 to 10 minutes, and may be severe and very painful. The pupil is dilated, but so far as known, no other organs are involved. The cramps are commonly accompanied by signs of heat prostration. This, however, is not necessarily so, there often being absolutely no thermal disturbance.
The treatment is in general that of heat prostration. Immediate relief may be obtained by sudden slapping of an affected muscle. For mild cases, immersion in a warm bath is recommended. Apomorphine in sub-emetic doses is said to confer immediate relaxation.
Treatment
With heat stroke we have a condition in which every moment lost before the institution of proper treatment reduces the chances of recovery. The two important measures are reduction of temperature and elimination of toxic material. For the former ice packs or ice baths are the most efficient. When the temperature starts down it may fall with great rapidity and collapse result. Consequently when giving[468] these ice packs or baths the treatment should be discontinued when the temperature by rectum reaches about 103°F., the patient then being removed from the bath and covered with a blanket. If the temperature again shoots up the ice bath can be repeated. Many have reported great benefit from the use of enemata cooled with ice. Some prefer to apply ice to the head and rub the body with pieces of ice. This can be carried out on a rubber sheet placed on a cot. If there is no ice available a sheet wet in dilute alcohol, plus the effects of a current of air from the electric fan or otherwise, may be tried. In a case with marked cyanosis venesection may be necessary. In asphyxial types of sun stroke prolonged artificial respiration is indicated.
Above has been noted the inefficiency of ice in reducing temperature and the far greater effect from evaporation, brought about by directing the current from a fan on the body covered with a wet sheet.
To promote elimination of toxic products venesection plus the use of intravenous injections of normal saline is the best treatment. In those terrible paralytic type cases which show a mortality of more than 50% it is well to think of acidosis and give slowly about a liter of a 1 or 2% solution of sodium bicarbonate. (See under treatment of cholera.) The use of alkaline enemata often gives good results, about a liter of a solution containing 2% of sodium chloride and 2% of sodium carbonate or bicarbonate.
As soon as possible after the more urgent hydrotherapeutic methods have controlled the case we should give calomel followed by salines. The coal tar products should be avoided as far as possible, from the danger of cardiac depression.
In the nonfebrile heat prostration the treatment is entirely eliminative and stimulant. The patient should be placed on his back in a cool shady place and tight clothing released, particularly about the neck. Rubbing the limbs as for any syncope-type affection, with hot water bottles if the collapse is marked, should be one line of treatment. Many give a little aromatic spirits of ammonia or whiskey but a hypodermic of strychnine would be better in a severe case.
Calomel and salines should be given after cardiac weakness disappears. To avoid these dangers of the tropical heat one should keep the body clean to promote good action of the sweat glands. The clothing should be light and loosely fitting and should permit a free circulation of air to assist evaporation. There does not seem to be any indication for the wearing of orange-colored clothes as the actinic rays are apparently unimportant. Puntoni recommends green-colored clothing for neck and spine. The green cloth should be covered with white material.
The head and nape of the neck should be protected by a light well-ventilated helmet. Alcohol should be avoided, or at any rate absolutely so, until evening. Water or lemonade should be taken freely and a siesta in the middle of the day is an important conserver of one’s resisting powers.
CHAPTER XLII
CLIMATIC BUBO, AINHUM, GOUNDOU, JUXTA-ARTICULAR
NODULES AND VISCERAL MYCOSES
Climatic Bubo
General Considerations
The naval surgeons of various countries have for many years been interested in a condition where inguinal buboes develop which have no relation to venereal infection.
All attempts to find any organism in these lesions have so far failed. Cultures from excised glands or from the necrotic centers of such glands fail to show any growth.
Stained smears and India ink preparations alike fail to show any causative organism. The Wassermann test is also negative. The disease seems much more common in the West Indies than elsewhere, statistics showing it to be about 10 times as often contracted by sailors in those waters as by crews in the seaports of China. In a recent article Rost states that he thinks there is evidence to show that the disease is contracted by sexual intercourse with prostitutes of the colored races. Of his 17 cases all had exposed themselves in this way.
Children never show climatic bubo and it seems peculiarly to affect the young adults composing the crews of ships. Even among the native prostitutes such a condition does not seem to exist and climatic bubo does not affect the male natives.
There may or may not be a periadenitis but there is thickening of the capsule and fibrous septa of the glands. At times an apparently healthy gland may show a necrotic centre, the contents of which, however, will be found to be sterile. One often notes in sections haemorrhagic infiltrations and oedema in the region of the peripheral lymph sinuses. A point of differentiation from ambulant plague buboes is the great increase in plasma cells in climatic bubo. It will be remembered that Cantlie suggested that climatic bubo was an attenuated plague but this idea has never been accepted. It has been suggested that malaria might cause climatic bubo.
Symptomatology
The period of incubation is a rather long one, Rost in a well-controlled case noting a period of at least five weeks. The onset is very gradual, so the first intimation of a swelling in the groins may be when a sense of heaviness is noted in that region after prolonged work. For this reason they have been called “fatigue” glands.
The glands of one side of the groin are usually involved although the swellings may affect both sides. The deep iliac glands also often show marked increase in size but the glands of the other parts of the body, as axillary or cervical, are practically never involved.
The swollen glands are only slightly tender and at first are discrete and not attached to skin or underlying tissues. Later on with the development of a periadenitis they may be firmly attached. In size they are usually as large as a hen’s egg but may become much larger.
The overlying skin is as a rule normal and one may at times palpate a soft center in an otherwise hard gland. Fever tends to come on as an irregular remittent type and I have seen cases showing temperature curves covering periods of two or three months which were not unlike those of Malta fever. With increase in size of the buboes there would be a two or three weeks’ rise to be followed, with the subsidence of the swelling, by lysis and later on to be renewed with reappearance of the bubo.
Climatic bubo runs a protracted course and does not respond at all well to treatment. The cases often develop a moderate secondary anaemia, which is most often noted in the relapse cases.
Diagnosis and Treatment
The history aids in differentiating gonorrhoeal, chancroidal and syphilitic buboes. There is not the hardness and marked absence of tenderness we get in syphilitic inguinal glands, and the reddened overlying skin of the other veneral buboes should differentiate.
Plague buboes are exquisitely tender and the patient usually manifests signs of extreme illness. In climatic bubo the patients rarely seem sick.
Surgical treatment is usually recommended and some advocate a radical enucleation of all glands in the region involved as we find at times apparently normal glands to show necrotic centers. My objection to enucleation is that the deep iliac glands are also often involved and it is not only impossible to remove all affected glands in such an inaccessible region but the surgical risks of wounding the deep veins are great. I have seen this accident occur more than once. Again the radical removal of all glandular structures in the groins, with subsequent scar tissue formation, obstructs lymph return so that elephantoid conditions result.
Rest in bed and hot compresses are of value when periadenitis sets in. When softening occurs the aspiration of the pus with an aspirating syringe and the subsequent injection of glycerite of boroglycerine containing 10% of iodoform are to be recommended. Some apply ointment of ichthyol, others pressure by shot bags. X-ray treatment has been recommended.
Emily strongly recommends the injection of 3 or 4 drops of iodoform ether (5%) into the center of the enlarged gland. This effects a rapid cure. The author also employs other measures such as rest in bed, wet compresses, and light mercurial ointment inunctions over the bubo at night.
Ainhum
General Considerations
This disease, equivalent clinically to a spontaneous amputation of the little toe, has been chiefly noted in the natives of the West Coast of Africa, especially among the Kroomen and in Brazil. Cases have been reported from the West Indies and rarely from the Southern States of the United States. It does not attack white people and the susceptibility of black races is probably connected with their tendency to keloid development.
There have been all sorts of suggestions as to etiology: (a) that it is related to leprosy, (b) that it is a tropho-neurosis, (c) that it results from wearing constricting bands or rings on the toe, (d) that it is connected with frequent injuries to the under surface of the little toe.
Pathologically we find a fibrous cord which has replaced the bony structures normally attaching the toe to the foot. We have, according to Unna, a ring-form sclerodermia with thickening of the epidermis causing an endarteritis with the production of a rarefying osteitis.
The disease is chiefly found in male adults between twenty-five and thirty years of age.
Symptomatology and Treatment
In 90% of cases the little toe is the one affected, more rarely the fourth toe or very rarely both the fourth and little toe. The little toes may be attacked at the same time but the condition usually first starts in one toe. At first we have a crack in the digito-plantar fold of the little toe. This extends laterally and finally appears on the dorsum. The distal portion of the toe enlarges and becomes bulbous so that it looks like a small potato. The connection between the foot and the bloated-looking toe is a limp fibrous cord which permits the[472] toe to wabble in various directions and to interfere greatly with walking.
The course of the disease extends over several years if the toe is not amputated by cutting through the fibrous pedicle or as the result of ulceration from injury to the pedicle.
Goundou
General Considerations
This is a disease which almost exclusively affects the black race and is chiefly found in the West Coast of Africa, where it is called big-nose or dog-nose. It is also found occasionally in China and the Malay Peninsula.
The prominent root of the nose is due to exostoses from the nasal processes of the superior maxillary bones.
Nothing definite is known as to etiology. Suggestions have been made that it is connected with yaws, syphilis or leprosy. Again that it is due to rhinoscleroma. Maclaud thought the hypertrophied tissues to be incident to irritation from dipterous larvae in the nasal fossae. Pathologically we have spongy bone covered by a thin layer of compact bone.
Symptomatology and Treatment
At first there is complaint of headache and an associated nasal discharge. At times the nasal passages may be obstructed by the developing growth, which however usually projects externally on both sides of the root of the nose just below the inner angle of the eyes. Breathing through the nose is not as a rule interfered with.
The bony exostoses develop in a downward and outward direction. The shape is generally oval. The disease commences in childhood and the bony outgrowths slowly increase in size so that by adult life they attain the size of a walnut. The overlying skin is normal and not attached to the bony tumor. As the tumors grow they tend to interfere with the vision of the patient. This is purely from obstructing the lines of vision as the growth does not usually invade the orbits. The treatment is entirely surgical and consists in chiselling away the bony outgrowth.
Juxta-articular Nodules
General Considerations
These nodular masses were first noted by Macgregor from cases in New Guinea but since then have been described from various parts of the tropical world.
These tumor masses were given the name juxta-articular nodules by Jeanselme, who studied the affection in natives of Siam. It may be stated that at present we know nothing definite as to etiology although several authors have reported fungi as the cause. This fungus has been stated to be a species of Nocardia. Some of the cases which have been reported would seem to be late manifestations of yaws.
Symptomatology and Treatment
These tumor masses vary in size up to that of a golf ball and are very hard in consistence. The skin over them is at first freely movable, but later on may become attached. They are located subcutaneously, especially about the external surfaces of the extremities and particularly in relation to the joints. They are not sensitive and rarely or never suppurate. The course is most chronic and but rarely do they become absorbed.

In those parts of Africa where the tumors due to Onchocerca volvulus are found there may be confusion in diagnosis but these filarial nodes are elastic. By aspirating the swelling microfilariae should be found in onchocerciasis.
The treatment of juxta-articular nodules is by excision should they give trouble.
Visceral Mycoses
The majority of cases of visceral mycoses reported from tropical[474] regions have been considered as caused by species of Monilia, but not infrequently fungi of the genus Cryptococcus have been incriminated. As a rule the mycosis is reported as occurring in cases which had been regarded as pulmonary tuberculosis. In some of the cases there were cutaneous lesions, enlarged glands and even generalized conditions as well as lung involvement.
Among the fungi reported for the lungs we have: Rhizomucor parasiticum, Nocardia pseudotuberculosis, Aspergillus fumigatus, Penicillium crustaceum, Monilia tropicalis, Monilia candida, Cryptococcus gilchristi, Coccidioides immitis and various other species. A satisfactory study of the true nature of the causative fungi has been made in only certain instances and a scientific investigation of this phase of tropical pathology is desirable.
Bronchomoniliasis.—Castellani has used this designation for two types of cases in which various species of Monilia have been reported as causative. In one type the symptoms are mild with but slight impairment of health, there being only a cough with expectoration of muco-purulent sputum. No fever is present. In the severe type we have the symptomatology of pulmonary tuberculosis with abundant reddish-gray sputum. In both types the diagnosis is made by finding the fungi in perfectly fresh sputum. This should be cultured in a hanging-block culture using Sabouraud’s medium. The mycelium and budding forms can best be studied in such a preparation. Negative findings for tubercle bacilli are important in diagnosis. Potassium iodide is recommended in treatment.
Sporotrichosis.—The infection with various species of Sporotrichum usually gives rise to gummatous lesions along the lines of the lymphatics of the extremities. These tumor masses break down and discharge a yellowish-brown pus. Rarely the process generalizes, then often invading the lungs. Culturing of the pus or sputum is necessary for diagnosis. In cultures the sporothrix shows a narrow (2µ) mycelium with grape-like clusters of oval spores at the end of a filament. The treatment recommended is iodide of potash.
Blastomycosis.—The causative organism, Cryptococcus gilchristi, is found in the purulent discharge as oval to round, doubly contoured, budding yeast-like cells 10 to 16µ. In cultures we have formation of a mycelium resembling that of an oidium. The lesions may be solely cutaneous or generalized in which latter case the lungs are apt to be involved giving a condition resembling pulmonary tuberculosis.
Coccidioidal granuloma.—This is a very rare and fatal infection caused by Coccidioides immitis, a fungus somewhat similar in cultures to C. gilchristi but differing in tissues in that it gives rise to endogenous spore formation in the cells found in the granulomatous material. The spores are about 3µ in diameter and contained in a large cell (30-60µ) which does not bud. We may have skin lesions accompanying visceral involvement or the latter alone. When involving the lung the infection closely resembles pulmonary tuberculosis. The spores metastasize readily by way of the lymphatics involved and we may have a picture of pyaemia. Skin lesions, when present, are ragged and punched out. About 40 cases have been reported, chiefly from California.
PART II
DIAGNOSTICS OF TROPICAL DISEASES
CHAPTER XLIII
DIAGNOSTIC PROBLEMS AND PROCEDURES TOGETHER
WITH COSMOPOLITAN DISEASES IN THE TROPICS
In temperate climates we always keep in mind syphilis, tuberculosis and the pyogenic infections when a diagnosis is in question. In the tropics these conditions are just as common, if not more so, and added to them we have many other diseases with protean manifestations such as malaria, beriberi, leprosy, ancylostomiasis and other helminthic infections, pellagra and amoebiasis.
The common mistake made by the physician when he first arrives in a tropical country is to expect to deal chiefly with diseases designated tropical. Before going to any tropical country the most important preparation is the study of the statistical reports from that section, covering a number of years. Everyone taking up the study of tropical disease should first study the geographical distribution of such diseases and those practising in temperate climates should remember that the first question to be asked a man suspected of having a tropical disease is “Where have you been during the past months and years?” Then too the same question should be applied as to intimate associates of the patient.
We all know how rare it is in temperate climates to find definite pathological conditions in people who are apparently well. In such people a definite finding of a cause sufficient to account for an illness is usually the key to the diagnosis. With those from the tropics, however, it is different. A single individual may be found upon examination to have amoebiasis, malaria, filariasis and syphilis, yet none of these infections prevent him from following his usual occupation. When such a patient comes to a ward it requires a correlating mind to eliminate four or five definite diagnoses, and fix upon some disease which is common to both tropics and temperate climates, as for example, typhoid fever.
In diagnosis in the tropics it is necessary to have at one’s fingers’ ends the various physical signs and subjective symptoms more or less characteristic of every disease of man as well as the laboratory findings. It is only when one has at hand all obtainable information that the solution of the medical problem becomes possible.
Furthermore, it is necessary to be familiar with the fact that certain infections, which at times give rise to marked alterations in the health of a patient, may at other times, and in particular when different races of man are concerned, give rise to no recognizable interference with health. This is particularly true of certain[478] helminthological diseases, as for instance the slight effects often noted in hookworm infection in the African races as against the marked damage to those of the white race harboring such parasites.
While the medical man is apt to have superabundant energy during the first few months of his tropical service this later gives way to the opposite state and in particular to a lack of initiative. It is possible to do that which is absolutely demanded in the daily work, but this is along the lines of routine requirements and to the exclusion of new and difficult methods of diagnosis.
Consequently, while in possession of full energy and zeal one should cultivate thorough and modern methods of study of his cases and make these matters of routine, to use in the listless period to follow.
We do not usually fully appreciate the assistance the history of the present illness as well as personal and family history of a patient gives us, although it is generally recognized as the first line of approach in diagnosis. In the tropics, when dealing with natives, we have the difficulty of language to contend with as well as with native superstition and popular ideas as to nature and causation of disease. When employing a native interpreter it is always well to keep in mind the fact that such assistants will rarely admit of ignorance of the language of the medical man and, furthermore, they try to twist the answers of the patients to make them agree with what they may think is in accordance with the desire of the examiner. Again in carrying out the physical examination it is difficult to be certain that the findings as to location or degree of pain, sensations, or time of appearance of lesions, as well as data as to pulmonary, renal and alimentary tract disorders, are correct.
For these reasons it would seem advisable to reverse the ordinary methods of diagnosis when employed in the tropics. Instead of making a tentative diagnosis following the physical examination, and then confirming or adding to evidence with laboratory data, it is better to first secure the findings as to blood, faeces, urine, sputum, etc., and then check up such indications as to the diagnosis by a final and thorough physical examination.
This method of procedure has been criticised by some of my friends and in fact is a source of criticism on my part when, as a laboratory worker, I have been asked by a purely clinical colleague to make a routine laboratory examination of one of his patients without any previous study of the case on his part. Every laboratory man recognizes the assistance a tentative diagnosis on the part of the clinician gives him in that it suggests the examinations which should be gone into with particular care.
The present trend, even in temperate climate practice and always with the tropical internist, is to have familiarity with laboratory technique and interpretation as well as with the methods of physical diagnosis; consequently the tropical practitioner makes no dividing line between the diagnostic information obtained in the laboratory and that gotten at the bedside.
It is not difficult to train a native helper to make and stain good blood smears as well as to examine such preparations, and the same holds for the urine and faeces preparations. The skill in making preparations, the familiarity with pathological findings and the patience in studying a preparation on the part of these assistants is at times a matter of surprise. Thus in a few minutes the physician can check up these findings or the lack of findings and have them at hand to assist him in his study of his case.
Laboratory Examination.—In the laboratory the routine examination should embrace, first, a study of a stained blood smear. It is essential that the smear be well made and the Romanowsky stain used a good one.
While more difficult to make than a smear on a slide the cover-glass smear method of Ehrlich has the advantage that the white cells are more evenly distributed and consequently the differential count more reliable. Furthermore, after a little practice, one can approximate the white count of a patient by examining the stained smear with a low power objective (16 mm). In my experience I get a better general impression of a large mononuclear increase with the low power than I do with the oil-immersion. As a matter of fact one can make his differential count with a low power objective after some practice. Next, using a high dry or immersion objective, we search for malarial parasites. It must be remembered that even when there is nothing diagnostic in a stained blood smear there is much information to be obtained in the way of diagnostic exclusion. Furthermore, while looking over the preparation some diagnosis may suggest itself and there is nothing more important in diagnosis than to have possibilities of diagnosis in mind. It is often stated in connection with the diagnosis of liver abscess that one should always suspect liver abscess in a tropical patient and this will hold for other diseases and thus the careful examination of a blood smear may be suggestive if not diagnostic.
Next the faeces should be examined both in an ordinary preparation and in one mounted in Gram’s iodine solution.
In the preparation made from a particle of faeces, emulsified in salt solution, we can note any excess of fatty acids or soap crystals and lack of normal digestion of meat fibres as well as presence of ova of intestinal parasites. Again such a preparation is necessary for noting amoeboid activity of amoebae as well as for the motility of flagellates and Strongyloides embryos. In the preparation mounted in Gram’s iodine solution we have distinctly brought out the nuclear division of encysted amoebae, our most practical means of differentiating between the pathogenic and nonpathogenic amoebae. This method also brings out flagellate characteristics. Again, any undigested starch grains show up distinctly by reason of their blue color. Blood cells and yeast cells stain a golden yellow.
In the examination of the urine it is well to take up with a pipette the entire sediment from a centrifuged tube of urine and deposit it on a slide.
Examination with diminished illumination and using the two-thirds objective quickly enables us to ascertain presence and character of casts. This same sediment is then treated with Gram’s iodine solution and a cover-glass applied. Such a preparation, using the one-sixth objective, brings out distinctly the differentiation of pus cells from renal epithelium as well as showing clearly golden-yellow red blood cells. While centrifuging one can test for albumin. A qualitative test for sugar takes only a few moments to make.
These simple quick tests of blood, faeces and urine suffice for the preliminary laboratory work in a case. Following the physical examination we can carry out more elaborate laboratory tests as indicated by the tentative diagnosis obtained from the physical examination and preliminary laboratory investigations.
Physical Examination.—As regards the physical examination it must be remembered that in the tropics glandular enlargements and skin eruptions are so essential in diagnosis that the rule generally adopted in skin clinics should be adhered to, that is an inspection of the entire body surface, either by stripping the patient or removing clothing from one part at a time.
The sphygmomanometer is of value in the diagnosis of tropical affections as well as those of temperate regions. Similarly, functional tests of the heart and kidneys, basal metabolism determinations, chemical examination of the blood, and tests for acid-base equilibrium may give definite information—in one climate as in another.
Palpation is peculiarly important in the diagnosis of the enlarged spleen, liver and glands of many tropical affections as well as for mapping out intestinal thickenings. Again in going over the patient for outlining heart, liver, etc., palpatory percussion is more satisfactory than the usual mediate percussion.
I find the use of the entire palmar surface of the middle finger, gently tapped over the surface, to give better results than any other method. In this way the percussion note is well elicited and the sense of resistance most satisfactorily obtained. The use of the tips of the index, middle and ring fingers, with a piano playing stroke, also should be employed.
One should always determine the character of the reflexes. Of these the most important are the patellar and biceps ones. This latter reflex is normally rarely obtained.
The pupillary reactions also require little time for eliciting and are of much value in differentiating a peripheral neuritis from a cord lesion.
Cosmopolitan Diseases in the Tropics
In considering the matter of the general prevalence of disease in the tropics it has seemed advisable to present statistics from the standpoint of deaths rather than admissions for disease, the probability of accuracy in diagnosis being greater where there may be the assistance of an autopsy.
In the following table I have selected three tropical places under American sanitary control, the city of Manila, the city of Panama and the Island of St. Thomas, Virgin Islands. The statistics embrace the calendar years of 1918, 1919 and 1920 The statistics of Manila relate solely to the Filipino population resident in Manila, it does not include Americans or other nationalities. The Filipino population of Manila in 1920 was 263,386. The three years covered had respectively a death rate of 49.97, 28.66 and 27.48 per 1000.
| Place | City of Manila (Filipinos only) | City of Panama | St. Thomas, Virgin Islands of United States | ||||||
| Population | 263,386 | 60,500 | 10,191 | ||||||
| No. of deaths | 11,840 | 7,378 | 7,238 | 1,314 | 1,211 | 1,297 | 248 | 176 | 185 |
| Rate per 1000 | 49.97 | 28.66 | 27.48 | 21.41 | 19.73 | 21.44 | 24.33 | 17.27 | 18.15 |
| Calendar year | 1918 | 1919 | 1920 | 1918 | 1919 | 1920 | 1918 | 1919 | 1920 |
| Typhoid fever | 180 | 171 | 226 | 0 | 3 | 2 | 4 | 0 | 0 |
| Malaria | 64 | 46 | 75 | 14 | 10 | 4 | 1 | 1 | 0 |
| Smallpox | 837 | 31 | 1 | 0 | 0 | 0 | 0 | 0 | 0 |
| Measles | 16 | 3 | 12 | 2 | 0 | 1 | 0 | 0 | 0 |
| Whooping-cough | 7 | 0 | 5 | 1 | 7 | 2 | 0 | 1 | 1 |
| Diphtheria | 14 | 16 | 9 | 4 | 10 | 5 | 0 | 0 | 0 |
| Influenza | 424 | 42 | 31 | 7 | 1 | 29 | 8 | 1 | 0 |
| Asiatic cholera | 108 | 328 | 2 | 0 | 0 | 0 | 0 | 0 | 0 |
| Dysentery | 678 | 390 | 253 | 3 | 9 | 5 | 2 | 1 | 0 |
| Leprosy | 2 | 2 | 3 | 3 | 1 | 2 | 0 | 0 | 0 |
| Purulent infection and septicaemia | 26 | 23 | 28 | 9 | 9 | 7 | 0 | 1 | 0 |
| Tetanus | 82 | 83 | 84 | 3 | 2 | 1 | 1 | 1 | 0 |
| Pellagra | 0 | 0 | 0 | 6 | 5 | 5 | 15 | 4 | 0 |
| Beriberi | 551 | 324 | 548 | 1 | 2 | 1 | 0 | 0 | 0 |
| Tuberculosis of the lungs | 1,605 | 1,334 | 1,340 | 223 | 206 | 169 | 20 | 20 | 27 |
| Cancer and other malignant tumors | 80 | 73 | 65 | 26 | 34 | 44 | 6 | 11 | 6 |
| Alcoholism | 3 | 3 | 2 | 2 | 1 | 2 | 0 | 1 | 0 |
| Diabetes | 6 | 6 | 11 | 3 | 3 | 0 | 0 | 0 | 0 |
| Simple meningitis | 448 | 292 | 300 | 12 | 11 | 14 | 1 | 2 | 0 |
| Cerebral hemorrhage | 109 | 99 | 93 | 27 | 39 | 40 | 10 | 9 | 4 |
| Convulsions (infants) | 224 | 148 | 91 | 3 | 4 | 5 | 4 | 1 | 1 |
| Acute endocarditis | 46 | 29 | 28 | 17 | 14 | 7 | 0 | 1 | 2 |
| Organic diseases of the heart | 118 | 95 | 93 | 63 | 37 | 45 | 9 | 17 | 27 |
| Diseases of the arteries | 18 | 23 | 15 | 15 | 27 | 34 | 9 | 7 | 9 |
| Acute bronchitis | 975 | 335 | 630 | 34 | 14 | 17 | 0 | 0 | 0 |
| Chronic bronchitis | 286 | 331 | 235 | 4 | 1 | 3 | 0 | 0 | 0 |
| Broncho-pneumonia | 872 | 293 | 372 | 86 | 109 | 108 | 15 | 10 | 6 |
| Pneumonia | 220 | 86 | 101 | 60 | 62 | 59 | 5 | 8 | 8 |
| Diarrhoea and enteritis (under two years) | 642 | 365 | 365 | 156 | 136 | 162 | 13 | 4 | 11 |
| Diarrhoea and enteritis (over two years) | 429 | 253 | 164 | 9 | 16 | 13 | 9 | 4 | 5 |
| Acute nephritis | 159 | 88 | 102 | 18 | 21 | 14 | 0 | 1 | 1 |
| Chronic nephritis | 265 | 248 | 156 | 72 | 63 | 63 | 15 | 16 | 21 |
| Intestinal parasites | 16 | 12 | 5 | 0 | 2 | 0 | 1 | 0 | 0 |
| Congenital debility | 614 | 460 | 611 | 32 | 13 | 21 | 13 | 14 | 6 |
| Senility | 531 | 451 | 357 | 17 | 7 | 9 | 13 | 0 | 1 |
| 10,655 | 6,483 | 6,413 | 932 | 879 | 893 | 174 | 136 | 136 | |
The population of the city of Panama during the year 1920 was 60,500. The death rate during the years covered was 21.41, 19.73, and 21.44 per 1000, respectively.
It may be stated that the average population of the Canal Zone during 1920 was 27,459, with 242 deaths, giving a death rate of 8.81 per 1000.
The population of St. Thomas during 1920 is estimated at 10,191. The death rate during 1918 was 24.33, during 1919, 17.27 and during 1920, 18.15 per 1000.
The diseases in the table of deaths do not account for all the deaths, the others having been from other diseases, accidents, etc.
In studying the Manila statistical reports more in detail we note that during 1920 there were reported 64 cases of diphtheria, 387 of measles and 577 of typhoid fever. The reasons for the high death rate in 1918 are clearly seen, namely, the epidemics of influenza and smallpox. As is the case in nearly every epidemic of influenza, the increase in deaths from this disease was accompanied with a large increase in deaths from acute bronchitis and the various pneumonias, conditions that in many cases should have been ascribed to influenza. The smallpox epidemic during 1918 was brought under control by a very extensive vaccination campaign. Only one death from this disease occurred in 1920.
During 1920, there were reported in Panama 95 cases of diphtheria, 313 of influenza, 154 of measles, 9 of typhoid fever, 4 of scarlet fever, 14 of smallpox and 311 of tuberculosis.
During the same period there were reported in St. Thomas 6 cases of chickenpox and 40 cases of tuberculosis. No cases of influenza, smallpox, measles or typhoid fever occurred. From reports for the year of 1921, it is noted that an extensive although not severe epidemic of measles has been present in the Virgin Islands during said year.
From the above tables we note that as far as actual causes of deaths are concerned the cosmopolitan diseases play a more important rôle than those we designate tropical diseases. Tuberculosis ranks first, other respiratory infections come a close second. Organic diseases of the heart and other degenerative diseases, such as chronic nephritis, are also noted for their frequency. The gastro-intestinal infections, typhoid fever, dysentery, diarrhoea, probably serve as a barometer of the sanitary conditions of a city.
But there are many other diseases whose importance from an economic standpoint may not be fully appreciated from mortality tables. Notable among these are venereal diseases, malaria, filariasis, yaws and hookworm diseases. Further it may be noted that many diseases without being the direct cause of death have a distinct bearing on the mortality. Amongst these we note particularly the various worm-infestations. The experience in Bilibid prison is an illustrating example. The mortality amongst the prisoners dropped markedly after the inmates had been cured of their various worm conditions.
Rheumatic Fever and Scarlet Fever.—From a study of the statistical reports and from the writings of various authorities there would[483] seem to be two cosmopolitan diseases, which are of extreme rarity in the tropics, rheumatic fever and scarlet fever.
It is true that in the Gold Coast report for 1911 there are noted 614 cases of rheumatic fever with one death.
There does not, however, appear to be any striking increase in admissions for valvular disease of the heart as would naturally be expected.
In Calcutta, in 1911, there were 74 deaths from rheumatic fever.
As regards scarlet fever, statistical reports from various parts of the tropical world fail to show cases.
In a report from Shanghai, which can hardly be considered as a tropical city, there is a statement that this disease first made its appearance in 1900, since which time it has spread among the Chinese, exhibiting marked virulence. Again in a Basutoland report there were quite a number of cases reported (67), but as this colony is in the extreme south of Africa it could hardly be called tropical.
Typhoid Fever.—When reliance for diagnosis rested almost solely on clinical manifestations, it was held that typhoid fever was rare or unknown in the tropics.
Since the advent of laboratory methods of diagnosis it has become known that typhoid and the paratyphoid fevers are quite common. The paratyphoid infections are more common in the tropics than in the temperate regions. The fever course and clinical picture of typhoid in the tropics are distinctly atypical. It was formerly common to consider cases of typhoid as malaria and in the southern states of the United States it was a common thing to diagnose typho-malarial fever.
Of course, latent malaria is apt to flare up in a person sick with typhoid, but the idea that there was a symptom-complex partaking of the characteristics of typhoid fever and malaria is now classed with historical data.
It is a remarkable fact that in many of the cities of the Orient conditions favoring infection with typhoid fever, such as neglect of the most elementary measures of disposal of faeces and lack of safeguarding of water supplies, exist and yet the natives seem to have an immunity to organisms causing alimentary tract diseases. It must be that such immunity is acquired by attacks of the disease in childhood. Certainly, Europeans in such communities have no protection unless they are vaccinated. It must be remembered that the protection from vaccination against the enteric group of bacteria can be relied on for not longer than a period of two years.
It would seem that typhoid fever in tropical countries is more serious than in temperate climates—thus the death rate in India is about twice as great.
In the absence of laboratory tests the chief reliance in the clinical diagnosis of typhoid should rest in the rather gradual onset of a continued fever, with a rather apathetic toxaemia. Of course atypical cases may have a fairly abrupt onset. An important point in the diagnosis is the rather slow pulse rate for the temperature elevation.
Marris Atropine Test.—Manson-Bahr regards the Marris atropine test as of the utmost value in the diagnosis of the enteric group of fevers. In this test one gives a hypodermic injection of grain 1/50 of atropine sulphate. Should the case be typhoid or paratyphoid the pulse rate is practically uninfluenced during the period from 25 to 50 minutes after the injection. In other infections or in normal individuals, the pulse rate drops at first but after 10 or 15 minutes rises to exceed the pulse rate before the injection by 30 or 40 beats during the period of 25 to 50 minutes following the injection.
In the laboratory tests the prime reliance must be placed in blood culture, which of course should be made during the first ten days of the illness. Blood cultures give positive results in the inoculated as well as in those not protected by vaccination.
Agglutination tests are the ones of choice after such a period, but one must discount agglutination in those who have been vaccinated previously. Of course the rising agglutination titre during the course of the disease gives valuable information, and the Dreyer technique, where simultaneous tests are made on emulsions of typhoid, paratyphoid A and paratyphoid B at intervals of 4 days, noting a distinct rise for one of these organisms, is based on this factor. At the same time this technique is exacting and does not seem to have given the results that were at first expected.
Culturing the urine is of more value in diagnosis than that of the faeces. Bacilluria may be expected in about one-fifth of cases after the second week. Faeces culturing gives positive results in a smaller proportion of cases and is attended with much difficulty.
The Paratyphoid Fevers.—The paratyphoids would seem to be more prevalent, in proportion to typhoid, in the tropics than in temperate climates, thus in India, of 1886 British soldiers, convalescent from enteric fevers, 791 were diagnosed as typhoid, 633 as paratyphoid A, 136 as paratyphoid B and 326 as enteric cases of uncertain etiology. Paratyphoid B cases seem more frequent in temperate climates than paratyphoid A ones, as noted during the war in France. Cruickshank, and Lafrenais, in a study of carriers, among the 1886 cases noted above observed that 49 became carriers and of these 34 were from paratyphoid A cases, 9 from typhoid convalescents and 6 from paratyphoid B convalescents. Of 13 chronic carriers (those carriers excreting organisms after a period of six months) 8 were carriers of paratyphoid A, 4 of typhoid and 1 of paratyphoid B.
This evidence would indicate that paratyphoid A, once introduced, would spread more widely than the other enteric affections.
Clinically, paratyphoid A cases resemble typhoid ones rather closely, although as a rule less severe in course. With paratyphoid B the course is less severe than with the other enteric organisms but it often shows an abrupt onset and is frequently similar to cases of meat poisoning. This organism and the Gärtner bacillus are common excitants of the so-called ptomaine poisoning cases. Paratyphoid B cases show a tendency to localize in the pelvis of the kidney or elsewhere and may cause a broncho-pneumonia.
Colon Infections.—Such infections seem to be rare in temperate climates other than as localized conditions especially of the urinary bladder. Cholecystitis is not infrequently due to a colon bacillus infection. In the tropics, however, especially following bacillary dysentery, we may have a generalized infection which may result[485] in a fatal septicaemia. In such cases abscess formation in the kidneys is usually found.
Cases diagnosed as mild typhoid fever have as a result of blood cultures been found to occasionally be due to a colon bacteriaemia.
In temperate climates as well as in the tropics pyelitis is often due to a colon infection and probably 10% of cases of appendicitis are caused by the colon bacillus alone, although it is extremely frequent in association with streptococci or staphylococci.
Bacillus alkaligines faecalis infections. Cases similar to typhoid fever have been found to be due to infections with this member of the typhoid-colon group of organisms.
Tuberculosis.—The negro race seems to possess a greater susceptibility to tuberculosis than the white one, a fact well recognized in the United States, where the colored population suffers far more severely than their white neighbors. The yellow races also show marked susceptibility to the scourge and in the Philippines it is easily the greatest cause of death.
In tropical regions the natives of the sea-level regions suffer more than those of the mountain plateaus and where the humidity is high rather than in arid sections. Thus tuberculosis is very rare or almost unknown in the dry desert-like regions of upper Egypt and the Sahara desert.
The disease gains headway in the rainy season and diminishes in prevalence during the dry season.
One factor in the great spread of the disease is the intimate contact of natives living together in a small room.
It is generally recognized that susceptibility is greater in childhood and that infection by way of the alimentary tract is common in children.
When one notes the habit of expectorating anywhere and everywhere on the part of people untrained in hygienic rules, it is easy to recognize the opportunity babies and young children have of ingesting tuberculous material taken up on their hands while they are crawling about.
During the war there was a great deal of tuberculosis among the native African troops serving in France, and a study of the disease in these men has furnished us information as to the existence of two clinical types among them. In the soldiers from Morocco and Algiers, the type observed was similar to that occurring in Europeans, and this was explained on the basis of the opportunity that had been given the people of the areas from which the troops came to acquire tuberculosis from contact with white colonists and during a period of many years to have acquired a certain degree of resistance to the invasion of the tubercle bacillus.
In connection with the Senegalese troops and some others coming from sections of Africa where tuberculosis was rare or nonexistent another type was observed which corresponded with the tuberculosis one sees in a young child or a guinea pig.
In these cases the disease starts with enlargement of the glands at the roots of[486] the lungs. This finding of course would require an X-ray plate but it was found that the enlargement of the supraclavicular glands at a point near the insertion of the sternocleidomastoid was one of the best early signs. The glandular stage lasted about five to ten weeks during which time the general health did not seem to be materially impaired. Following this stage and lasting only about two weeks or up to two months a stage of generalized tuberculosis sets in with fever, emaciation, caseous pneumonia or manifestations of miliary tuberculosis. There was no tendency to fibrosis or cure of the process, death almost invariably occurring. Borrel, who studied the disease in these natives, states that if put at rest and placed on a generous diet, while the case is in the glandular stage, one-half of them may recover. It was noted that sputum examinations of these cases were almost invariably negative.
Smallpox.—This disease may justly be considered the greatest scourge of the natives of tropical countries. It is responsible for much of the blindness noted in natives of sections where vaccination has not been employed.
In some of the countries of the Orient smallpox kills more people than cholera, plague and dysentery together. Many reports have shown that as many as 80 to 90% of a native population may be attacked in an outbreak and of these practically one-half die. In such communities the disease is more one of young children, the adults possessing a certain degree of immunity from attacks in childhood during previous epidemics. It has frequently been noted that the native colored races do not seem to acquire as marked an immunity as is observed among the white races of temperate climates following an attack of the disease. Again it has been insisted that the immunity following vaccination is not as marked as that obtaining in European countries. This point would seem not well founded because efficient and universal vaccination has apparently caused smallpox in the Philippines to be of no more importance than it is among any other well vaccinated people. It is striking to note the great number of pitted faces among adult Filipinos, whereas this condition is practically absent in the generation following the general vaccination introduced by the Americans.
In tropical natives the most severe forms of smallpox are observed—confluent and haemorrhagic.
Opportunities for the spread of the disease are most favorable in many parts of the tropical world by reason of intimate association, religious festivals and pilgrimages.
Under the name alastrim or Kaffir milk-pox, a disease similar to a mild form of smallpox has been reported from Africa and the West Indies. Various points were raised to differentiate it from smallpox, but in a recent epidemic in Jamaica and Haiti proof was adduced to demonstrate its identity with smallpox. In Haiti the epidemic was controlled by vaccination with smallpox vaccine, and those individuals exposed to the infection but properly vaccinated, uniformly escaped. Among the soldiers of the Marine Corps in Haiti there were only two cases and these occurred in men who gave no evidences, of successful vaccination.
Varicella.—This disease is of common occurrence in the tropics and does not seem to give rise to greater mortality than it does in temperate climates.
In the Philippines I have been struck by the resemblance it bears to cases of varioloid, inasmuch as we frequently note as numerous lesions on the face as on the body. In fact I have been sure that the pustular lesions of the face of such cases were those of smallpox, until I noted typical varicella lesions on the body.
Mumps.—This disease is found in many parts of the tropics and presents similar features to the epidemic parotitis of temperate climates.
In the Philippines there seem to be cases similar to mumps but without the contagious feature so characteristic of the disease in Europe.
Glanders.—This rare disease of Europe and the United States seems to be much more common in many tropical countries. In the Philippines it generally shows itself in the acute form and is much dreaded by reason of its great infectiousness.
Diphtheria.—Formerly there was an idea that diphtheria, like scarlet fever, was extremely rare or unknown in the tropics.
The assistance of the laboratory has shown that this old idea is incorrect and that the disease is fairly prevalent in many tropical regions.
Vincent’s Angina.—While not rare in temperate climates, various affections of the oral mucous membrane due to the fusiform bacillus in symbiosis with various species of spirilla are fairly common in the tropics. The best known condition is one in which the tonsils show somewhat the appearance of a follicular tonsillitis but ulceration is more common and severe, with however, less evidence of toxaemia.
The temperature in a case of pure Vincent’s Angina rarely exceeds 101°F. but if there is a mixed infection with other pyogenic organisms the temperature and other signs of a severe infection may be more marked. There is usually more or less swelling of tributary glands. Associated with the angina or alone we may have a gingivitis in which the spongy gums more or less resemble those of scurvy or of pyorrheoa alveolaris. In fact these Vincent organisms have been considered as factors in the development of pyorrhoea alveolaris. In the tropics there have been many reports of organisms of the type of those described by Vincent occurring in skin ulceration or affection of the mucous membranes other than the oral ones, more particularly the pudendal mucous membranes.
The infections are readily and easily diagnosed by a smear stained with any simple aniline dye. Care must be taken not to accept such a finding as the sole cause, as an underlying diphtheria, syphilis or other dyscrasia may be more important.
Malignant Tumors.—It is usually stated that malignant tumors are very rare among tropical natives. The proper solution of this question, however, is complicated by the frequent lack of careful autopsies.
Pneumonia.—Just as with the tubercle bacillus so does the black race seem to have less resistance to the Pneumococcus than does the white one.
Great engineering works employing tropical natives are frequently associated with very fatal epidemics of pneumonia, especially broncho-pneumonia. Again in the black races the infection tends to become generalized rather than localized in the lungs. It is more toxic and insidious in its course than is true of the infection in the white man; it has the fatal trend of pneumonia of the aged. Another tendency is to invasion of the meninges.
Influenza.—In temperate climates we associate this disease with bronchial and coryzal manifestations. In the tropics types almost unrecognized in Europe are noted, especially the gastro-intestinal and nervous ones. The similarity in the clinical picture of dengue with slight eruption and tropical influenza is striking.
During the recent pandemic of influenza there was a frequent complication of influenza pneumonia; many of these influenza bronchopneumonias resembled plague pneumonia.
Tetanus.—This infection is far more prevalent in tropical than in temperate climates. It is particularly fatal to infants, the infection occurring from errors in the dressing of the cord at the time of childbirth.
Syphilis and Other Venereal Diseases.—Syphilis is rampant in many parts of the tropical world. Jeanselme has noted that syphilis among tropical natives often starts with an extra-genital lesion which tends to become phagedenic and that the secondaries are but slightly marked. It is in the tertiary stage that the disease shows itself in its malignancy.
All tropical workers have noted the absence of tabetic and paretic manifestations in the native syphilitics. LeDantec notes that he has not observed parasyphilis in any European who had contracted syphilis from a native woman and brings up the question of a difference in strains of syphilis.
The American Naval Surgeons at Guam and Samoa have been struck with the absence of primary lesions of syphilis among the natives of these islands and Butler has suggested that this is due to an immunity received as result of contracting yaws in childhood. There certainly are many reasons for considering syphilis and yaws as closely related.
Soft chancre is common in many tropical seaports and shows itself in a rather virulent form. In particular it is apt to be complicated by suppurating buboes.
In tropical gonorrhoea it would seem that involvement of the testicles is more common than in temperate climates.
Endocrine Disturbances.—Internists in all parts of the world are beginning to appreciate that many of the puzzling complaints of ill-health are connected with abnormal functioning of the ductless glands. The conditions resulting from excessive or diminished functioning of the thyroid gland are well understood and the determination of the basal metabolism rate is now a standard laboratory procedure. There are many types of apparatus on the market and the determination is within the reach of any hospital staff.
Hyperthyroidism is now rarely unrecognized as is also true of myxoedema but sub-states of thyroid functioning are less frequently recognized.
McCarrison has stressed the importance of endocrine disturbances in dietetic deficiencies and notes atrophy of all the glands of internal secretion in such conditions with the exception of the adrenal which tends to hypertrophy. There is possibly some hypertrophy of the pituitary in males. The oedema which accompanies most of the food deficiency diseases he associates with the adrenal enlargement and hyperactivity of function, although oedema does not invariably result from such hypertrophy. In pellagra there is a low blood pressure, possibly due to adrenal hypofunction. Goitre is found in many parts of the tropical world and Castellani states that this disease is met with frequently in Ceylon and various regions of Africa. Disturbances of the internal secretion of the pancreas, resulting in diabetes, are common in parts of Asia.
Determination of Basal Metabolism.—In the study of cases where abnormal thyroid functioning is suspected the most accurate method of such determination is by estimating the percentage of the patient’s metabolism as above or below the normal average.
Basal metabolism is that caloric value which an individual produces while resting in bed and prior to taking breakfast—in other words when the effects of food and exercise on caloric output are least operative. Basal metabolism is expressed in terms of calories per hour per square meter of body surface. It varies with different ages. It is proportionate to body surface which is calculated from the height and weight of the individual. Normally this metabolism should not vary more than 15% above or below accepted normal figures. The use of the respiration calorimeter is the most accurate method for determination of heat production but it has now been found that the oxygen consumption during short periods gives data for calculation[490] of such heat production (indirect calorimetry). In the Benedict portable respiration apparatus the patient breathes into and out of a confined volume of air circulating through a series of purifiers which remove the carbon dioxide. A determination of the volume of oxygen consumed is made from the decrease in the total air volume. The heat production resulting from the absorption of one litre of oxygen is relatively constant whether used to burn fat or carbohydrate and gives an accurate index of total heat production. The Benedict apparatus can also be employed for determining carbon dioxide excretion and thereby giving data for the respiratory quotient. The determination of the heat produced in the excretion of carbon dioxide is less accurate although easier of determination. In marked cases of hyperthyroidism the basal metabolism ranges 75% above the normal figures, between 50 and 75% for severe cases and less than 50% for mild cases. In hypothyroidism the figures are usually 20 to 40% below the normal averages. The average respiratory quotient is taken as O.82 and the calorific value of oxygen at this respiratory quotient is 4.825 per litre. We multiply the litres of oxygen by 4.825 to compute the heat output. It must be remembered that patients with high fever give 30 to 40% heat production over normal figures. Severe cardiac and renal conditions as well as leukaemias also give high values. The average calorie output per square meter of body surface per hour based on the Du Bois “height-weight” formula, is 39.7 for man and 36.9 for women between the ages of 20 and 40, being greater in youth and less beyond forty.
Focal Infections.—In recent years our attention has been directed to the importance of certain localized bacterial foci which may extend through blood or lymph channels and give rise to various systemic or localized diseases. Most important of these diseases are various types of arthritis together with endocarditis, myocarditis and pericarditis. Next in importance are renal infections, chiefly of the glomerulonephritis type.
Cholecystitis, appendicitis, pancreatitis and various skin lesions may also have origin in a focal infection. The primary foci may be localized in any part of the body but those seated in the tonsilar, peridental membrane, nasal and accessory sinus tissues are the most common and important. Focal infections of the genito-urinary tract may also give rise to generalized conditions as is also true of such foci in the alimentary tract. In the tonsils we should particularly examine the material of crypts for various streptococci and likewise the bacterial flora of tooth abscesses or pyorrhoea alveolaris.
Table Showing Number of Times Each Focus Was Considered a Probable Source of Infection in a Series Studied by Billings and Associates
| No. | No. | ||
| Tonsil | 336 | Prostate and genito-urinary tract | 24 |
| Teeth | 136 | Gallbladder | 3 |
| Sinus | 12 | Enterocolitis | 2 |
| Bronchi | 5 | Appendix | 1 |
| Uterus and tubes | 12 | Middle ear | 1 |
CHAPTER XLIV
ONSET AND THE TEMPERATURE CHART IN THE DIAGNOSIS
OF TROPICAL DISEASES
While a knowledge of the variations in type and course of the body temperature in the various tropical diseases is of great value in diagnosis, yet such information is liable to lead one astray, unless such data are controlled by a careful consideration of the other and, in my opinion, more important factors of physical diagnosis and laboratory examinations.
The idea that there is a scientific exactness in the employment of the clinical thermometer tends to make one overestimate its value in diagnosis.
It must be remembered that the high air temperature one encounters in the tropics affects the clinical thermometer, which is of the maximum type. This is particularly true when the sun may be shining on the container in which the thermometer may be kept. Even if one shakes down the column of mercury before putting it in the mouth, the glass of the instrument will quickly cause the mercury column again to rise. It should be a practice to place the instrument in cool water before inserting it in the mouth and we must not forget that a sufficient retention in the mouth, from two to five minutes, should be insisted upon before accepting the temperature reading.
For practical purposes we may divide tropical diseases, from a standpoint of body temperature, into two classes. (1) Those diseases in which the absence of fever in the general course of the illness is the rule, and (2) those diseases in which the presence of fever in the general course of the illness is the rule.
Nonfebrile Diseases.—Among the nonfebrile diseases we may note the following: Beriberi, sprue, pellagra, cholera, leprosy, amoebic dysentery, hookworm disease, filariasis, bilharziosis, endemic haemoptysis or paragonomiasis, liver fluke disease, malarial cachexia, yaws, verruga, oriental sore and ulcerating granuloma of the pudenda, as well as the various tropical skin diseases.
One should always keep in mind the fact that a latent malaria often gives way to frank malarial manifestations when some intercurrent disease still further reduces the body resistance. This is not infrequently the explanation of a febrile onset in the course of a disease typically afebrile. In the tropics if a fever chart does not show a[492] characteristic periodicity one can often obtain indications of periodicity even in a continued or remittent fever course by the greater elevation of temperature every third day (tertian periodicity).
Another disease which often flares up following conditions which lower vitality and giving rise to fever and manifestations of toxemia is tuberculosis, a disease as common in the tropics as elsewhere. Then too, one must always keep in mind febrile manifestations not unrarely marking syphilis. This triad of diseases, malaria, tuberculosis and syphilis, must always be thought of, as well as septic conditions, when fever is present in a disease typically afebrile.
There are certain exceptions in the above list which may be here noted.
Beriberi.—There has been considerable discussion as to whether a disease with fever and a rash, but otherwise resembling wet beriberi, is the same disease or a distinct disease entity. The fever in epidemic dropsy; as it is called, is rarely over 102°F., usually ranging from 99° to 101° and accompanying the dropsy.
Pellagra.—While there may be slight variations from the normal yet the ordinary case of pellagra fails to show a distinct febrile course, so much so that the appearance of fever in a case of pellagra makes for an unfavorable prognosis. In the so-called typhoid pellagra, an acute, rapidly fatal form of the disease, a high temperature curve may be obtained. At the same time this condition has been noted by Italian and German writers as being present in patients not showing any rise in temperature. It is possible that the development of enteric fever in a pellagrin may at times be the explanation of the fever.
Cholera.—Instead of a favorable stage of reaction there may set in a condition with low muttering delirium, dry brown tongue and with an elevated temperature, the so-called typhoid state, which is speedily fatal.
Rarely a rise of 3 or 4 degrees which does not last more than forty-eight hours may be present in a stage of reaction going on to a favorable convalescence.
It must be remembered that the rectal temperature in the majority of cases of cholera may show elevation of temperature approximating 100°F., while the axillary temperature may be as low as 95°F. When there is a great difference between the rectal and axillary temperatures, instead of the more common 4 or 5 degrees of a typical case of cholera, the prognosis is bad. The temperature taken by mouth may be as low as 86°F.
Leprosy.—Among the prodromata of leprosy, along with epistaxis, feeling of great weakness, somnolence and occasional sweats, there may be recurring attacks of fever. These are at times diagnosed as malarial manifestations. With the appearance of typical lesions the course is apt to be nonfebrile with the exception that febrile accessions often accompany the early macular manifestations.
Amoebic Dysentery.—Unless complicated by hepatitis or some bacterial infection of the amoebic lesions the disease progresses without fever.
Sprue.—While sprue is certainly one of the most typical of afebrile diseases yet a form of sprue is recognized which begins as an acute entero-colitis with fever. This must be most exceptional, or only a coincidence, as sprue is characterized by a very insidious onset.
Ancylostomiasis.—The occasional reports of fever being present are probably connected with bacterial infection at the site of attachment of the hookworm.
Filariasis.—There is a febrile manifestation of filarial disease which is attended by rigors and high fever. This is a lymphangitis which causes an erysipelatous appearance about the region involved. It is these recurring attacks of lymphangitis which gradually lead to the enormous thickening of the skin characteristic of elephantiasis. Such attacks are designated elephantoid fever. They are often diagnosed as malarial chills and in Barbadoes, where there is no malaria, such attacks are called “ague.”
Lymph scrotum is the filarial condition in which elephantoid fever is most frequently noted.
Schistosomiasis.—In the vesical type of the disease we may have as a complication a pyelitis which could give rise to febrile manifestations. In Japanese schistosomiasis the disease sets in with fever and urticaria. Before this combination of symptoms was recognized as belonging to schistosomiasis we designated it urticarial fever.

Malarial Cachexia.—Attacks of an irregular type of fever are frequently noted in the malarial cachectic, especially setting in upon some exposure to dampness or chilling, to alcoholic excesses or to excessive fatigue. Cases are also met with in the tropics, particularly among natives, where fever plays no apparent part in the profound anaemia of these ague-cake victims. It is this absence of fever which many consider the evidence of immunity to malaria in the native with his anaemia and large spleen.
Such cases often show crescents in their blood and act as reservoirs of virus for mosquito infection.
Latent Malaria.—Following treatment, or even when quinine has not been exhibited, cases of malaria often cease to show clinical symptoms or even laboratory findings until a relapse develops in case a cure has not been effected. As noted elsewhere, these relapses, in which the febrile manifestations are prominent, often follow exposure to tropical sunlight, wetting, etc. Besides such frank manifestations, we may have numerous symptoms, that exhibit periodicity, arising in the course of nonfebrile latent malaria.
Yaws.—While fever of a more or less irregular type frequently occurs at the onset of both primary and secondary stages, especially just before the secondary general eruption, yet the course of yaws as it runs over months or years is afebrile.
Verruga.—The recent views as to verruga being a separate condition, and not the secondary stage of a typhoid-like fever, Carrion’s disease, removes from its clinical features the fever characteristics generally noted.
Diseases with Subnormal Temperatures.—There are certain diseases in which marked lowering of the temperature may be a feature of some stage.
The algid stage of cholera is that which gives to cholera the picture of a living death with the cadaveric features and icy breath. Again in the choleraic type of algid pernicious malaria we may have a subnormal temperature.

In infections with Shiga’s bacillus of bacillary dysentery we may have cases showing extreme toxaemia with algid manifestations and a subnormal temperature.
During the last stages of sleeping sickness a lowering of the temperature is fairly constant.
In heat prostration the temperature tends to be subnormal. Clinically this condition with its pale clammy skin is just the opposite of heat stroke with its turgid countenance and hyperpyrexia.
In the Indian type of relapsing fever we may have a fall to subnormal temperatures at the time of the crisis of the first paroxysm, often attended with manifestations of collapse.
Sprue cases tend to run a subnormal temperature during the terminal period.
Febrile Diseases.—The diseases in which the presence of fever, in the general course of the illness, is the rule, may be considered in two groups:
1. Those in which the temperature chart is of prime importance in diagnosis.
2. Those in which the character of the fever gives but little assistance in diagnosis.
Diseases in Which the Temperature Chart Is of Prime Importance In Diagnosis
Benign Tertian and Quartan Malaria.—The presence of a fever of tertian or quartan periodicity is absolutely characteristic of malaria. In rare cases however of meningococcus sepsis, without cerebral localization, we may have a tertian or even quartan periodicity. Such cases are apt to show petechial spots and blood cultures give the diagnosis. There is also a polynuclear leukocytosis. As the result of the introduction by infected mosquitoes, on successive days, of two generations of malarial parasites in benign tertian or of three generations in quartan malaria, a quotidian periodicity may obtain.
Such a type of fever is observed in tuberculosis, liver abscess and various pyogenic infections. The rise of temperature in benign tertian and quartan malaria takes place in about one-half the cases somewhat early in the day, while the daily rise in tuberculosis, septic conditions and liver abscess, is more apt to occur in the evening, the evening rise being almost the rule in such diseases. Hectic fevers generally show a less distinct cycle of chill, hot stage and sweating than do the benign malarial paroxysms. At the same time the enlarged spleen, presence of parasites in the peripheral circulation and response to quinine are diagnostic points in malaria which must always be thought of. When quinine administration has caused the parasites to be temporarily absent from the blood the increase of large mononuclears is very suggestive.
Dengue.—In this disease the extremely sudden onset with a fever rising rapidly to 104°F. or more and remaining elevated for three or five days, to fall by crisis to normal and, after an apyrexial period of one or two days, to be succeeded by a second febrile accession, gives a fever chart which is quite characteristic—the saddle-back chart.
The typical dengue eruption does not appear until towards the end of the primary fever or about the commencement of the secondary one. Intense postorbital soreness is a striking feature in dengue. The comparative slowness of the pulse may be noted in dengue as well as in yellow fever. Leucopenia and polymorphonuclear percentage reduction are rather characteristic.
Relapsing Fevers.—These fevers, when there are three or more relapses, can perhaps be more easily diagnosed from the temperature chart alone than is the case with any other disease, excepting malarial fevers showing tertian or quartan periodicity. With an abrupt rise of temperature, which remains elevated for from three to seven days and drops by crisis to normal, to be followed by approximately a week of normal temperature, with two or three repetitions of the fever and[496] apyretic intervals we have an extremely characteristic temperature chart.
Unlike malaria and yellow fever the onset is apt to be towards evening rather than in the morning hours.
The spleen is apt to be enlarged during the pyrexia and less so when the temperature is normal. The spirochaetes are to be searched for while fever is present as they disappear from the peripheral circulation during the apyretic intervals. In tick fever numerous relapses are frequent in the European and less common in the native.
Malignant Tertian Malaria.—While benign malarial infections are more common in temperate climates malignant tertian is the one which usually prevails in the tropics.
While the Italian designation of this type of fever as aestivo-autumnal has more general acceptance yet Koch’s term, tropical malaria, is eminently appropriate. The onset in malignant tertian is rather insidious so that the case may be suspected as one of typhoid fever. At the same time the first paroxysm is apt to show a tertian periodicity while subsequent ones, by only remitting, and not showing an intermission, give the temperature picture of a continued fever in which periodicity is not easily noted. At the same time a study of such a chart will probably show that the curve tends to approach normal every other day. The suggestion of periodicity is almost of as great value as the actual drop to normal in the intermission. The remittent or even continuous type of fever in malignant tertian tends to yield to an intermittent one after a week or more of such fever.
Very characteristic of malignant tertian paroxysms is that they set in with chilly sensations rather than a frank chill. It is for this reason that the so-called “dumb chill” is recognized as more serious than the frank unmistakable chill.
The main feature of malignant tertian paroxysms is the pronounced and prolonged hot stage, which frequently lasts from twenty to thirty-six hours and may run over into the rising temperature connected with the development of the succeeding generation of parasites.
The terms anticipation and postponement are frequently used to explain the drawn-out fever of this type of malaria.
There is great irregularity in time of development so that we get the impression of completed cycle before the accepted forty-eight hours as shown by a rising temperature within thirty-six hours—anticipation; or, instead of showing indications of a completion of cycle in forty-eight hours the fever still keeps up—retardation.
The descent of the fever curve is much more gradual than the rise at the onset of the paroxysm. The fine hair-like rings of the tropical parasite are the only schizont stages usually found in the peripheral blood. As the rings enlarge they fail to appear in the peripheral blood so that blood examination at such times will be negative. The finding of crescents is proof of a malignant tertian infection.
In view of the fact that one is likely to fail to find parasites just before or just after a paroxysm search should particularly be made for the pigment-carrying phagocyte—the melaniferous leucocyte.
In certain of the pernicious manifestations of malignant tertian, especially the hyperpyrexial type of cerebral malaria, the temperature may reach a very high degree, 107°F. to 110°F., and it is often mistaken for sun stroke by one not familiar with the fact that so-called sun stroke is often only this fatal form of malaria.
In algid pernicious malaria the axillary and, in particular, the rectal temperature remain elevated even with a subnormal surface temperature.
The infection in latent malaria is most often a malignant tertian one. Such cases often develop paroxysms following surgical operations or at time of pregnancy or childbirth. Clark has noted the abundance of parasites in smears from the placenta taken at time of delivery when the peripheral blood showed few or no parasites. Such an examination is of enormous value in differentiating a malarial paroxysm from puerperal sepsis.
Malta Fever.—In this disease, in which the wave-like febrile periods during every three or four weeks are so characteristic as to give it the name of “febris undulans,” there is a very insidious onset. For a week or ten days the temperature climbs up step-ladder-like and then descends in like manner to be followed by a few days of apyrexia with succeeding similar relapses. The case would suggest an attack of typhoid with relapses.
The course of the disease is attended by rather marked anaemia and physical and mental depression. Very characteristic are the fleeting joint pains which involve chiefly the knees, hip, ankle and shoulder joints. There are pain and some swelling but without redness. Neuralgic pains are also common. There is often a bronchitis which, when associated with the rather common night sweats of the disease, is suggestive of phthisis.
The cardiac muscle seems to be especially liable to the toxic effects of the disease so that a weak heart and intermittent pulse are often noted. It has a very protracted course of, on the average, about four months.
An astonishing fact is that so severe and a prolonged fever should give such a slight mortality (2%).
Occasionally, a case shows a high continued or remittent fever and aggravated symptoms, going into a typhoid state. Such cases are often fatal. There is an increase in the lymphocytes but no increase in total leucocytes.
The wave course of the fever, with afebrile intervals and increasing anaemia, is suggestive of kala-azar, particularly when there is a greater enlargement of the spleen than is usual in the disease. Ordinarily the splenic enlargement about corresponds to that of typhoid fever but at[498] times it may be so much enlarged as to suggest the splenic tumor of kala-azar.
Diseases in which Fever is an Important Feature but Gives Little Assistance in Diagnosis
Kala-azar.—This disease has a peculiarly insidious onset because, with a fairly high remittent fever, it may cause but slight feeling of illness in the patient.
Rogers insists upon the importance of taking the temperature every four hours so that one may note the fact of there being two distinct rises in the twenty-four hours instead of the single evening rise of typhoid fever.
At first it is confused with malaria as well as typhoid. The spleen becomes greatly enlarged by the third or fourth month and later on we also have enlargement of the liver. Periods of fever and apyrexia occur irregularly and over a period of months or even longer than a year.
There is a marked leucopenia and the presence of the leishman-donovan bodies, often in huge numbers, in the juice from spleen or liver puncture, makes for a certain diagnosis.
Yellow Fever.—With a sudden onset and rapidly rising fever, which often occurs in the early morning hours, in a patient who has gone to bed feeling well, we have a markedly congested face and neck with injected conjunctivae and intense headache and backache. The fever tends to remain elevated for about three days after which there may be noted a fall in temperature or even an intermission. This, which has been termed the period of calm, is often slight and of short duration. About this time the jaundice and haemorrhages show themselves and the temperature tends again to rise although less marked than with the sthenic fever of the first two or three days. Of great importance is the fact that the pulse rate falls with a maintained temperature or does not increase in rate as the temperature rises (Faget’s law). A very slow pulse is quite characteristic of yellow fever after the third day.
Important in the diagnosis of yellow fever from bilous remittent fever and blackwater fever is the absence of splenic enlargement in the former. In particular must it be remembered that jaundice does not show itself in yellow fever until about the third day, following which we may have bleeding from the gums and black vomit.
Melaena and haematuria may also be noted. The presence of a marked albuminuria is one of the leading characteristics of yellow fever.
Blackwater Fever.—The onset is usually quite sudden with a rather severe chill and marked lumbar pain.
The temperature rises rapidly to about 104°F. and may fall in a few hours to a point but little above normal accompanied by profuse sweating. The fall in temperature is not followed by a feeling of improvement. On the other hand there may be a fever course of remittent or even continuous type. That which is most characteristic and which in the majority of cases enables the patient to make his own diagnosis is the passage of dark or porter-colored urine.
The urinary sediment is simply granular débris, there are no intact red cells. It is a haemoglobinuria and not a haematuria. If there is any blood in the urine in yellow fever it is in the form of a haematuria. The urine in both blackwater fever and yellow fever is highly albuminous. In some cases the haemoglobinuria seems to result from quinine administration alone, in which case there is not the high fever of typical blackwater fever. As distinguishing it from yellow fever we have a marked jaundice which comes on in a few hours or even with the first appearance of haemoglobinuria instead of being delayed until the third day, as in yellow fever. Again, the blackwater paroxysm is intensely prostrating, it is markedly asthenic, while the onset of yellow fever is quite sthenic in character. The enlarged tender spleen of blackwater fever is also a prominent feature, which is absent in yellow fever. Bilious vomiting is an early and severe feature of blackwater fever but not the black vomit of yellow fever which does not come on until after the third day.
The jaundice of bilious remittent fever does not appear before the second day and the urine shows bile pigments instead of haemoglobin.
Plague.—The fever rapidly rises, so that the maximum temperature of 104°F. or more may be attained on the first day of the disease. In general the type of fever is continuous with a rather marked remission about the third day, following which, the fever again goes up with the appearance of the glandular involvement (bubonic plague).
In fatal cases the temperature may shoot up just prior to death. The drawn anxious countenance, the mental state and speech as of one suffering from alcoholic intoxication, and the early cardiac involvement, with very weak and irregular pulse, give one a clue to plague even before the buboes appear. Smears and cultures from the buboes make the diagnosis.
In plague pneumonia there is nothing characteristic about the rather continuous fever which sets in suddenly and continues elevated until death, which generally occurs about the third or fourth day. The marked mental involvement, the extreme illness of the patient, with but slight physical signs of the involvement of the lungs, should make one suspect a plague pneumonia during an epidemic. The abundant, rather watery sputum, which later becomes sanguineous, gives us[500] a diagnosis by reason of its being loaded with bipolarly stained plague bacilli. This material should be rubbed on the shaven abdomen of a guinea pig to make the diagnosis absolutely sure.
In septicaemic plague, if such be considered a distinct type, there is very little that is manifest except a fever in a profoundly ill person. The powers of resistance may be so overwhelmed that the temperature response is slight and the chart not show temperature records above 100°F. or 101°F. Blood cultures make for the diagnosis in septicaemic plague.
Typhus Fever.—While the classical temperature chart is usually described as one with a rapid rise, reaching the maximum of 103° or 104° by the second day, with a fastigium of twelve to fourteen days, followed by a critical fall, yet many cases recently observed in the Balkans show a fairly gradual onset with a fall by lysis.
A stuporous condition with, about the fifth day, a rash first appearing about abdomen and flanks, to soon become petechial, are important in diagnosis. There is a leucocytosis with marked acid staining of the granules of the polymorphonuclears.
Trypanosomiasis.—The fever of trypanosomiasis is markedly irregular and may exist in natives without preventing them from carrying on their duties as porters. The onset is on the whole insidious.
In this first stage of trypanosomiasis or trypanosome fever, when trypanosomes are found only in the glands and peripheral circulation, what may probably be considered as leading peculiarities of the fever are the great daily oscillations, a normal morning temperature being succeeded by an evening rise up to 102°F. or 104°F.
While the febrile course is usual in Europeans it is often absent in natives. With them the febrile manifestations are noted in the sleeping sickness stage.
Again a very rapid, low tension pulse is present, whether the temperature be low or high. These febrile accessions are followed by apyrexial intervals.
Extremely important in diagnosis are the glandular enlargements of which those of the upper posterior cervical triangle are the most characteristic (Winterbottom’s sign). Gland juice is more apt to contain trypanosomes than the smear from the blood. Deep hyperaesthesia is also a very characteristic symptom (Kérandel’s sign).
When the trypanosomes are found in the cerebro-spinal fluid we have the second stage of trypanosomiasis or that of sleeping sickness. This is ushered in by a tremor of the tongue and mental symptoms of great apathy and listlessness. An irregular fever is present at times during the course of this stage of sleeping sickness but toward the end of the disease the temperature tends to be subnormal.
Progressive weakness and emaciation with finally a comatose state are features of the terminal weeks.
Brazilian Trypanosomiasis.—The disease begins acutely in young children with an irregular remittent fever. The parasites are not apt to be found except during the fever. The lymphatic glands become swollen. With repeated accessions of fever, followed by apyrexial intervals, the child becomes weaker and more anaemic. The spleen is enlarged. This infection is very fatal for children.
In adults the disease tends to assume a chronic type and often, from involvement of the thyroid, gives symptoms of myxoedema.
Bacillary Dysentery.—The onset may be quite sudden and the temperature rise to 102°F. or 103°F. There is apt to be some evidence of toxaemia as shown by headache, slight flightiness and gastric upset. The dysenteric stool is of a whitish, mucopurulent appearance and flecked or streaked with blood rather than showing the uniformly brownish or greenish gelatinous material of amoebic dysentery.
In very severe bacillary dysentery algidity may come on with a cold clammy skin, reminding one of cholera. At such times the temperature is subnormal.
Liver Abscess.—In the so-called pre-suppurative stage of amoebic hepatitis the only symptom may be an irregular remittent fever of moderate degree. This and a leucocytosis may be the only points noted.
In fully developed liver abscess we have a painful liver which is enlarged upward often with pain referred to the right shoulder and a crepitation at the base of the right lung. The fever is distinctly hectic in type with an evening rise and associated with profuse sweatings. The evening rise of temperature does not usually tend to exceed 102°F. and apyrexial intervals are frequently observed in the fever chart.
It must be remembered that liver abscess has been found at autopsy where fever had not been noted. A sensation of chilliness often accompanies the evening rise of temperature.
Heat stroke.—The onset may be as sudden as in apoplexy, although there are usually prodromata of dizziness and headache. The patient is unconscious with dry burning skin, labored or stertorous breathing, and a temperature of from 107° to 111°F.
The hyperpyrexial malarial paroxysm presents much in common with heat stroke.
Climatic Fevers.—From many parts of the tropical world there have been reported cases of fever supposed to be due to exposure to prolonged[502] action of tropical heat. They are often designated as climatic or inflammatory fevers.
A careful study of the clinical manifestations tends to show that many of them are much like dengue. Some may be due to infection with the Gärtner group of bacteria.
Rat Bite Disease.—Following a rather long incubation period of from six to eight weeks, during which time the bite has healed, we have a rather sudden invasion with high fever, 103° to 104°F., chill and at the same time inflammation of the site of the bite with lymphangitis and some swelling of tributary glands.
After two or three days of high fever we have a fall by crisis with profuse perspiration. The temperature remains normal for a few days during which time the local swelling and inflammation subside. The fever again comes on, frequently with an eruption, to later on disappear and reappear. At such times the fever course is irregular. There may be as many as 12 of these febrile accessions.
Tsutsugamushi.—The disease sets in about a week after the bite of the Kedani mite with headache, chills and fever of about 101°F. There is also pain in certain lymphatic gland groups which will be found to drain the area in which is located a small necrotic ulcer, the site of the bite of the mite. The temperature continues to rise during the next two or three days to 104°-105°F. and remains as a high continuous fever for about a week, when an eruption of irregular dusky macules appears, first on the face and later on chest, extremities and trunk. About the tenth day the fever begins to go down by lysis and the eruption fades. Injection of the conjunctivae is marked.
Certain authorities have considered that there is a striking clinical similarity and possible relation attaching to tsutsugamushi, Rocky Mountain spotted fever, trench fever and typhus fever. At present we believe that tabardillo or Mexican typhus is the same as the well-known typhus of temperate climates, hence that which describes typhus fever obtains for tabardillo.
Spotted Fever of the Rocky Mountains.—In tabardillo the onset and termination of the fever is rather abrupt while in spotted fever of the Rocky Mountains it climbs up gradually for a week to reach its maximum and falls by lysis.
All these diseases are characterized by a more or less stuporous state.
Oroya Fever.—It was formerly supposed that this fever was the first stage of verruga, but it is now considered as a distinct disease entity, caused by a protozoon of bacillary form which invades the red cells. With pains of various joints and bones we have a gradual rise of temperature which after a few days reaches 103° to 104°F. and tends to become remittent or continuous.
There is a remarkable and excessive destruction of the red cells which may fall to a million or less per c.mm. The fever after about three weeks begins to fall by lysis. Enlargement of liver, spleen and lymphatic glands are common. Pain over the bones, especially the sternum, is often excruciating.
Epidemic jaundice shows an irregular pyrexia of from 102° to 103°F. with jaundice about the second or third day.
Trench Fever.—Cases of varying types of fever, some charts more or less resembling the dengue ones, while others show repeated relapses of short duration, have been designated trench fever.
In tularaemia we have an irregular fever course of rather rapid onset, extending over two or three weeks. There is very little evidence of toxaemia. Convalescence is tedious.
Typhoid fever and the paratyphoid infections are far from uncommon in the tropics and present clinical courses at variance with those observed in temperate climates. The temperature charts in such cases are irregular and atypical.
It must be remembered that paratyphoid infections may show marked gastro-intestinal symptoms and that the rose rash of such cases tends to be far more profuse than that of typhoid.
Intestinal Parasites.—There are many conditions which seem to be productive of febrile attacks as evidenced by the disappearance of the fever upon removing such cause. Thus patients presenting abdominal distress and a fever of varying type may be completely relieved of all symptoms upon evacuating the larvae of various flies following purgation. This condition is designated intestinal myiasis.
Abdominal pains and fever may also be caused by various helminths usually considered nonsymptom-producing as has been noted in heavy Ascaris infections.
CHAPTER XLV
BLOOD EXAMINATIONS IN THE DIAGNOSIS OF TROPICAL
DISEASES
In a short chapter on such a large subject only the more important methods and findings can be considered. As regards interpretation of blood findings in various tropical diseases one may note in the recent work of Schilling-Torgau the difficulties which at present beset the subject. Until some universal agreement as to standard methods of technique and in particular complete accord as to the characteristics of the diagnostic cells can be arrived at, conflicting reports as to findings must of necessity be obtained.
In taking up this subject it has seemed convenient to divide it into 4 heads: (1) The microscopical examination of fresh preparations or stained blood smears; (2) blood culture methods; (3) serological examinations, and (4) other practical methods of haematological study.
In the companion volume on laboratory work I have endeavored to take up rather in detail the various methods and techniques but in this chapter I shall only give single methods or point out short cuts in well-recognized ones or make suggestions as to new methods of blood study which may eventually aid us in diagnosis.
Those who work in temperate climates cannot realize the difficulties which beset the tropical laboratory worker from the lack of proper assistance, damaging effects of heat and moisture on stains and media and, of greater importance, the impairment of that driving energy so necessary for the carrying out of complicated methods. A short and simple method has a far greater value in the tropics than at home.
Blood Preparations
To obtain blood, except for blood cultures, use either a platino-iridium hypodermic needle which can be sterilized in the flame, a small tenotome, or a surgical needle with cutting edge.
Needles should be sterilized by boiling since flaming dulls the edge. A steel pen with one nib broken off or the glass needle of Wright may also be used. To make a glass needle, pull straight apart a piece of capillary tubing in a very small flame. Tap the fine point to break off the very delicate extremity. Scarcely any pain attends the use of such a needle. In puncturing either the tip of the finger or lobe of the ear a quick piano-touch-like stroke should be used. The ear is preferable, as it is[505] less sensitive and there is less danger of infection. Before puncturing, the skin should be cleaned with 70% alcohol and allowed to dry. It is advisable to sterilize the needle before using it.
Note that in order to secure in the specimen a cell count that corresponds to that obtaining in the circulation as a whole it is necessary to massage the ear vigorously prior to making the puncture. Subsequently there should be no manipulation of the part, the blood examined being that which exudes freely. This procedure renders more likely the finding of blood parasites.
The first drop of blood which exudes should be taken up on the paper of the Tallquist haemoglobinometer, using subsequent ones for the blood pipettes and smears. If it is necessary to make a complete examination, it is rather difficult to draw up the blood in the pipettes, dilute it, and then get material for fresh blood preparations and films without undue squeezing, which is to be avoided. Of course, fresh punctures can be made. Ordinarily, complete blood examinations are not called for. It is only a white count or a differential count or an examination for malaria that is required.
As a practical point it is very rare that a red count is indicated. There is one point not sufficiently recognized by physicians and that is that a routine blood examination is not apt to be as carefully conducted as one calling for a specific feature. Without disparaging the necessity of routine examination of urine as well as blood it is a fact that the internist who knows what he wants gets better results from the laboratory man.
The Microscopical Examination of Fresh Preparations Or Stained Blood Smears
As regards haemocytometry it may be stated that in the tropics the counting of red cells is required more frequently in comparison to white ones than is the case in temperate climates where probably 100 white counts are necessitated as against 1 red count. This is on account of the frequency of secondary anaemias in the tropics.
The idea that time may be saved by making a white and red count from the same preparation is not borne out practically so that it is better to make white and red counts separately.
As a diluting fluid for red counts a normal salt solution, preferably about 0.9%, answers perfectly and if desired may be tinged with neutral red, methyl green or gentian violet to bring out white cells. When available, however, I prefer a 2½% aqueous solution of potassium bichromate for red cell counts.
Rulings.—The most desirable rulings are those of Türck, Zappert and Neubauer.

In these the entire ruled surface consists of nine large squares, each 1 mm. square. These are subdivided, and in the central large square are to be found the small[506] squares used for averaging the red cells. These small squares are 1/20 mm. square and are arranged in nine groups of 16 small squares by bordering triple-ruled lines. As the unit in blood counting is the cubic millimeter, if one counted all the white cells lying within one of the large squares (1 mm. square), he would have only counted the cells in a layer one-tenth of the required depth, so that it would be necessary to multiply the number obtained by 10. This product, multiplied by the dilution of the blood, would give the number of white cells in a cubic millimeter of undiluted blood. The Neubauer ruling is the most satisfactory.

Bürker Haemacytometer.—Some workers prefer the Bürker haemacytometer. In this there are two ruled wedge-shaped pieces of glass, separated at their bases, which take the place of the ruled disc of the Thoma apparatus. Two oblong pieces of glass are on either side of the ruled wedges and are 0.1 mm. higher, thus taking the place of the shelf. Clamps fix a cover-glass on these shelves giving a space 1/10 mm. over the ruled surfaces. The blood is run in by capillarity from the mixing pipette. I gave up this type of counter because the clamps made manipulation awkward.
Thoma-Levy Chamber.—In the Thoma-Levy modification of the Bürker apparatus the central portion of the slide is cut away and in this depression is cemented a rectangular strip of glass, divided by a central channel. Each half of this strip of[507] glass has a Neubauer ruling on it so that one can make a white count on one side and a red one on the other, simply touching the tip of the red pipette to the space separating the under surface of the cover-glass from the ruled rectangular slips on one side and then with the white pipette repeating the same on the other side. An advantage of the Thoma-Levy is that the original thickness of the slide makes the shelf on which the cover-glass rests instead of the support being strips on either side of the ruled surfaces and cemented to the slide. The Neubauer ruling is undoubtedly the most satisfactory of the haemacytometer rulings, its rulings being simpler than those of the Türck system. The unit square in all these haemacytometers is the small square for counting red blood cells, 1/20 mm. square.

To Make a Red Count.—Having a fairly large drop of blood, apply the tip of the 101 pipette to it and, holding the pipette horizontal, carefully and slowly draw up with suction on the rubber tube a column of blood to exactly 0.5. The variation of 1/25 of an inch from the mark would make a difference of almost 3%. If the column goes above 0.5, it can be gently tapped down on a piece of filter-paper until the 0.5 line is cut. Now insert the tip of the pipette into some diluting fluid, and revolving the pipette on its long axis while filling it by suction, you continue until the mark 101 is reached.
A variation of 1/25 of an inch at this mark would only give an error of about 1/30 of 1%. This gives a 1-200 dilution. After mixing thoroughly by shaking for one or two minutes, the fluid in the pipette below the bulb is expelled (this of course is only diluting fluid). A drop of the diluted blood of a size just sufficient to cover the disc when the cover-glass is adjusted, is then deposited on the disc and the[508] cover-glass applied by a sort of sliding movement, best obtained by using forceps in one hand assisted by the thumb and index-finger of the other.
In red counts we use exclusively the small 1/20 mm. squares which are in groups of 16 bounded by triple-ruled lines.
The depth of fluid over the ruled surface is 1/10 mm., hence each of these small squares is 1/10 × 1/20 × 1/20 = 1/4000 of a c.mm., so that it takes 4000 such spaces to equal the unit for blood counting (1 c.mm.). My practice in making red counts is to count the red cells in five of the groups of 16 small squares. This in normal blood is about 100 for the 16 squares. After counting 5 groups of 16 we have counted the red cells of 80 small squares which is 1/50 of 4000 (the number in the 1 c.mm. unit). For this reason 50 × 200 (the blood dilution) = 10,000, so that it is only necessary to multiply the number of red cells found in 5 groups of 16 small squares by 10,000 in order to obtain the number of red cells per c.mm. For more accurate determination the process can be repeated with a second or third drop of the diluted blood, which would give an average from 160 or from 240 small squares.
To Count White Cells.—Draw up the blood in the white pipette to the 0.5 line. Then, still holding the pipette as near the horizontal as possible, because the column of blood tends to fall down in the larger bore, draw up by suction a diluting fluid which will disintegrate the red cells without injuring the whites. The best fluid is 0.5% of glacial acetic acid in water. This makes the white cells stand out as highly refractile bodies. Some prefer to tinge the fluid with neutral red or gentian violet. The 0.5 mark is preferred because it takes a very large drop of blood to fill the tube up to the 1 mark and if there is much of a leucocytosis a 1 to 10 dilution is not sufficient.
The blood having been drawn up to 0.5, we have a dilution of 1 to 20.
Making a preparation, exactly as was done in the case of the red count, we count all of the white cells in one of the large squares (1 sq. mm.). The cross ruling greatly facilitates this. Note the number. Then count a second and a third square. Strike an average of the large squares counted and multiply this by 10, as the depth of the fluid gives a content equal to only 1/10 of a c.mm. Then multiply by the dilution.
Example.—First large square 50; second large square 70; third large square 60. Average 60. Then 60 × 10 × 20 = 12,000, the number of leucocytes in 1 c.mm. of blood. In order to save time the count is preferably made with a low power (⅔-inch objective) as the leucocytes stand out like pearls. It is more accurate, however, to use a higher power, so that pieces of foreign material may be recognized and not enumerated as white cells.
If one will accustom himself to comparing the distribution of the leucocytes in a well-made stained dried-blood film, prepared according to Ehrlich’s cover-glass method, with that in a haemacytometer preparation, he can readily acquire an experience which will enable him to determine with considerable accuracy the degree of leucocytosis by the examination of a stained, cover-glass preparation alone.
After making a blood count, the haemacytometer slide should be cleaned with soap and water and then rubbed dry, preferably with an old piece of linen. As the[509] accuracy of the counting chamber depends upon the integrity of the cement, any reagent such as alcohol, xylol, etc., and in particular, heat, will ruin the instrument. The pipettes should be cleaned by inserting the ends into the tube from a vacuum pump, as a Chapman pump. First draw water or 1% sod. carbonate solution through the pipette, then alcohol, then ether, and finally allow air to pass through to dry the interior. If the interior is stained, used 1% HCL in alcohol. If a vacuum pump is not at hand, a bicycle pump or suction by mouth will answer.
Preparations for the Study of Fresh Blood
Many authorities prefer a fresh blood specimen to a stained dried smear in the study of parasites of the blood. In malaria in particular there is so much information as to species to be obtained from a fresh specimen that the employment of this method should never be neglected. While waiting for the film to stain one has five or six minutes which could not be better spent than in examining the fresh specimen which only requires a moment to make.
Manson’s Method.—Have a perfectly clean cover-glass and slide. Touch the apex of the exuding drop of blood with the cover-glass and drop it on the center of the slide. The blood flows out in a film which exhibits an “empty zone” in the center. Surrounding this we have the “zone of scattered corpuscles,” next the “single layer zone” and the “zone of rouleaux” at the periphery. It is well to ring the preparation with vaseline. When desiring to demonstrate the flagellated bodies in malaria, it is well to breathe on the cover-glass just prior to touching the drop of blood.
The Method of Ross is very easy of application and gives most satisfactory preparations. Take a perfectly clean slide, and make a vaseline ring or square of the size of the cover-glass. Then, having taken up the blood on the cover-glass, drop it so that its margin rests on the vaseline ring. Gently pressing down the cover-glass on the vaseline makes beautiful preparations which keep for a very long time. If it is desired to study the action of stains on living cells, this method is also applicable. A very practical way to do this is to tinge 0.85% salt solution containing 1% sodium citrate (the same as is used in opsonic work) with methylene azur, gentian violet, or methyl green. With a capillary bulb pipette, take up one part of blood, then one part of tinted salt solution. Mix them quickly on a slide and then deposit a small drop of the mixture in the center of the vaseline ring and immediately apply a cover-glass and press down the margins as before. This method will be found of great practical value.
Preparation and Staining of Dried Films
When preparations are desired for a differential count, Ehrlich’s method of making films is to be preferred, as the different types of leukocytes are more evenly distributed. In making smears by spreading, there is a tendency for the polymorphonuclears to be concentrated at the margin while lymphocytes remain in the central part of the film.
Cover-slip Films.—In Ehrlich’s method we have perfectly clean dry cover-slips. Take up a small drop of blood without touching the surface of the ear or finger. Drop this cover-glass immediately on a second one and as soon as the blood runs out in a film, draw the two cover-slips apart in a plane parallel to the cover-glasses. Ehrlich uses forceps to hold the cover-glasses to avoid moisture from the fingers, but I find I can work more quickly and satisfactorily with the fingers alone. The method shown in Fig. 150 is a very convenient one. In making malarial smears it is better to wash the finger or ear with soap and water to get rid of all grease and dirt. Then dry thoroughly before puncturing. Alcohol is not so efficient.

Fig. 150.—1, 2, 3, 4, Making blood smears on slide. 5. Smear ready for staining—grease marks prevent Wright stain from running over slide. 6. U-shaped glass tubing to hold slide in staining. 7. Right hand holding two cover-glasses. One cover-glass is being touched to drop of blood from ear. 8. Cover-glasses transferred to left hand in preparing to place one cover-glass on another and spread film. 9. Separating cover-glasses by sliding one from the other.
Slides and spreaders should be absolutely clean and grease-free. Scrubbing with soap and water, thorough rinsing and drying, then subjecting the slide to the flame to make it grease-free is satisfactory.
For removing dirt and grease from skin, a mixture of acetone, 40; alcohol, 60; is the best and quickest means. A bottle is kept on hand, with the puncturing needle embedded in the stopper.
For cleaning a slide, nothing equals Bon Ami. Rub up some with the wet finger, rub the slide with the lather until there is a friction squeak; let dry; polish with a[511] clean, dry cloth. This is far better than soap and water, alcohol, ether and flaming combined. Note how a drop of water spreads on a glass so treated.
Smears on Slides.—Of the various methods of spreading films on slides, that described by Daniels is quite satisfactory. In this the drop of blood is drawn along and not pushed along. The films are even, can be made of any desired thickness by changing the angle of the drawing slide, and there is little liability of crushing pathological cells. Take a small drop of blood on the end of a clean slide. Touch a second slide, about ½ inch from end, with the drop and as soon as the blood runs out along the line of the slide end, slide it at an angle of 45° to the other end of the horizontal slide. The blood is pulled or drawn behind the advancing edge of the advancing slide. An angle less than 45° makes a thinner film; one greater, a thicker film.
Instead of a slide a square cover-glass may be used and if the edge be smooth it makes a more satisfactory spreader than the slide.
Instead of the Daniels method I prefer to take up the drop of blood on the slide on which the smear is to be made, about ½ inch from the end. Then apply the spreader slide and so soon as the drop runs along the end of the spreader slide proceed as above described. This method is shown in Fig. 150.
Spreaders.—Of the various methods of making smears by means of cigarette paper, rubber tissue, needles, etc., the best seems to be to take a piece of capillary glass tubing and use this instead of a needle in making the film. There is one advantage about the strip of cigarette paper touched to the drop of blood and drawn out along the slide or cover-glass, and that is that it is almost impossible not to make a working preparation by this method.
Thick-film Methods
Such methods are of the greatest practical value in searching for malarial parasites when they are in very small numbers in the peripheral circulation, in finding trypanosomes, relapsing fever spirochaetes and filarial embryos. Ruge’s method so brings out the polymorphonuclears that such a technic can be used for opsonic index. Many workers prefer the Ross thick-film method in examining for malaria. In this about one-half of a drop of blood is smeared out over a surface about equal to that of a square cover-glass and allowed to dry. It is then flooded with 1/10 of 1% aqueous solution of eosin for about fifteen minutes. The preparation is then gently washed with water and then treated with a polychrome methylene-blue solution. After a few seconds this is carefully washed off and the preparation dried and examined.
James smears out an ordinary drop of blood so that it makes a circular smear about ¾ inch in diameter. This may be easily accomplished with a spatulate toothpick. When dry, treat the blood smear with alcohol containing HCl (Alcohol 50 cc., HCl 10 drops) until the haemoglobin is dissolved out. Then wash thoroughly in water for five or ten minutes. Allow to dry and then stain as ordinarily with the Wright or Giemsa stain.
Ruge’s Method.—The best thick-film method is that of Ruge. After the blood has dried well gently move the slide about in a glass containing a 2% solution of formalin to which has been added 1% of glacial acetic acid. After laking is completed, as shown by disappearance of brown color, treat the slide in the same way in a glass of tap water to remove all traces of acid. Next wash gently in distilled water and stain with dilute Giemsa (1 drop to 1 cc. of water) for twenty to thirty minutes. Wash in water and allow to dry without heat or blotting paper. Some workers prefer to stain the dried thick smear for one hour in a jar containing dilute Giemsa stain (1 to 40) without previous fixation or dehaemoglobinization. At present, I make my thick films by taking up a large loopful from the exuding drop of the puncture wound.
This is deposited at one end of the slide and from it three or four more daubs are made in succession toward the other end of the slide. These daubs are quickly smeared out before coagulation takes place in the first daub.
With all thick-film methods it is extremely important to have thorough drying of the smear before dehaemoglobinizing or staining. This ordinarily requires one or two hours in the air or twenty to thirty minutes in the incubator. It is particularly important in working with such smears, although holding for ordinary smears, to protect them from flies, ants, etc., as such insects will eat up the smear in a few minutes if left exposed.
Fixation of Film.—In Wright’s, Leishman’s, and other similar stains the methyl-alcohol solvent causes the fixation. In staining with Giemsa’s stain, or haematoxylin and eosin, separate fixation is necessary. For Giemsa either absolute alcohol (ten to fifteen minutes) or methyl alcohol (two to five minutes) answers well.
For haematoxylin and eosin, heat gives the best results. The best method is to place the films in an oven provided with a thermometer. Raise the temperature of the oven to 135°C. and then remove the burner. After the oven has cooled, take out the fixed slides or slips.
One of the handiest methods is to drop a few drops of 95% alcohol on the slide or cover-glass. Allow this to flow over the entire surface; then get rid of the excess of alcohol by touching the edge to a piece of filter-paper for a second or two. Then light the remaining alcohol film from the flame and allow the burning alcohol to burn itself out.
Staining Blood-films.—As separate staining with eosin and methylene blue rarely gives good preparations and as the modifications of the Romanowsky stain recommended are easy to make and employ, and give much greater information, the separate method of staining is not recommended.
Wright’s Method.—The stain is made by adding 1 gram of methylene blue (Grubler) to 100 cc. of a ½% solution of sodium bicarbonate in water. This mixture is heated for one hour in an Arnold sterilizer. The flask, containing the alkaline methylene-blue solution should be of such size and shape that the depth of the fluid does not exceed 2½ inches. When cool, filter the methylene blue solution, and add 500 cc. of a 1 to 1000 eosin solution (yellow eosin, water soluble). Add the eosin solution slowly, stirring constantly until the blue color is lost and the mixture becomes purple with a yellow metallic lustre on the surface, and there is formed a finely granular black precipitate. Collect this precipitate on a filter-paper and when thoroughly dry (dry in the incubator at 38°C.) dissolve 0.3 gram in 100 cc. of pure methyl alcohol (acetone-free). Wright lately has recommended using 0.1 in 60 cc. methyl alcohol. This constitutes the stock solution. For use filter off 20 cc. and add to the filtrate 5 cc. of methyl alcohol.
A modification by Balch is very satisfactory. In this method instead of polychroming the methylene blue with sodium bicarbonate and heat, the method of Borrel is used. Dissolve 1 gram of methylene blue in 100 cc. of distilled water. Next dissolve 0.5 gram of silver nitrate in 50 cc. of distilled water. To the silver solution add a 2 to 5% caustic soda solution until the silver oxide is completely precipitated. Wash the precipitated silver oxide several times with distilled water. This is best accomplished by pouring the wash-water on the heavy black precipitate in the flask, agitating, then decanting and again pouring on water. After removing all excess of alkali by repeated washings, add the methylene-blue solution to the precipitated silver oxide in the flask. Allow to stand about ten days, occasionally shaking until a purplish color develops. The process may be hastened in an incubator. When polychroming is complete, filter off and add to the filtrate the 1 to 1000 eosin solution and proceed exactly as with Wright’s stain.
In Leishman’s method the polychroming is accomplished by adding 1 gram of methylene blue to 100 cc. of a ½% solution of sodium carbonate. This is kept at 65°C. for twelve hours and allowed to stand at room temperature for ten days before the eosin solution is added. The succeeding steps are as for Wright’s stain.
In all Romanowsky methods distilled water should be used. If not obtainable, the best substitute is rain-water collected in the open and not from a roof.
Method of staining:
1. Make films and air dry.
2. Cover dry film preparation with the methyl-alcohol stain for one minute (to fix).
3. Add water to the stain on the cover-glass or slide, drop by drop, until a yellow metallic scum begins to form. It is advisable to add the drops of water rapidly in order to eliminate precipitates on the stained film. Practically, we may add 1 drop of water for every drop of stain used.
4. Wash thoroughly in water until the film has a pinkish tint.
5. Dry with filter-paper and mount.
Red cells are stained orange to pink; nuclei, shades of violet; eosinophile granules, red; neutrophile granules, yellow to lilac; blood platelets, purplish; malarial parasites, blue; chromatin, metallic-red to rose-pink.
Giemsa’s Modification of the Romanowsky Method.—This is one of the most perfect of the modifications. The objection is that greater time in staining films is required than with the Wright or Leishman method and the stain is very expensive.
Take of Azur II eosin 0.3 gram. Azur II 0.08 gram.
Dissolve this amount of dry powder in 25 cc. of glycerine at 60°C. Then add 25 cc. of methyl alcohol at the same temperature. Allow the glycerine-methyl alcohol solution to stand overnight and then filter. This is the stock stain. To use: Dilute 1 cc. with 10 to 15 cc. of distilled water. If 1 to 1000 potassium carbonate solution is used instead of water it stains more deeply. These same dyes, mixed with methylene violet, are now obtainable commercially as a powder ready for solution in methyl alcohol.
The alkaline diluent is used to obtain the coarse stippling in malignant tertian (Maurer’s clefts). Having fixed the smear with methyl alcohol for one to five minutes, pour on the diluted stain, and after fifteen to thirty minutes wash off and continue washing with distilled water until the film has a slight pink tinge. For Treponema pertenue stain from one to twelve hours.
Haematoxylin Staining.—While the Romanowsky methods are more satisfactory for differential counts and for the demonstration of the malarial parasites, and especially for differentiating species, yet by reason of the liability to deterioration in the tropics of methylene blue the haematoxylin methods may be preferable. Many workers in blood-work and cytodiagnosis prefer the haematoxylin.
1. Fix the film either by heat, with methyl alcohol for two minutes or with Whitney’s fixative. Heat is to be preferred.
2. Stain with Meyer’s hemalum or Delafield’s haematoxylin for from five to fifteen minutes according to the stain. Frequently three minutes will be found sufficient. To make the hemalum, dissolve 0.5 gram of haematin in 25 cc. of 95% alcohol. Next dissolve 25 grams of ammonia alum in 500 cc. of distilled water. Mix the two solutions and allow to ripen for a few days. The stain should be satisfactory in two or three days.
3. Wash for two to five minutes in tap water to develop the haematoxylin color.
4. Stain either with a 1 to 1000 aqueous solution of eosin or with a one-half of 1% eosin solution in 70% alcohol. The eosin staining only requires fifteen to thirty seconds.
5. Wash and examine.
Differential Count
In making a differential count I would recommend the following from the directions of Schilling-Torgau. It will be remembered that considerable interest was raised a few years ago in what was termed the Arneth index. In this the more normal, more mature, better resisting[515] polymorphonuclears were considered to have 3 or 4 lobes to the nuclear structure, even occasionally 5. The immature cells had only one or at most two lobes to the nucleus. The index was obtained by adding the percentages of cells showing 1 and 2 lobes to ½ the percentage of those with 3 lobes. As will be understood a high percentage of these immature cells was unfavorable in prognosis. These cells are graded from left to right, I, II, III, IV, V, as to separate masses in the nucleus, so that when the percentage is shoved or displaced to the left it indicates an increase in the immature cells.
Schilling-Torgau divides his polymorphonuclears into: (1) The myelocyte which is always of course a pathological cell. (2) The immature form polymorphonuclear. In this there is a close resemblance to the neutrophile myelocyte but there is a nuclear indentation instead of the round nucleus of the myelocyte. It is this cell which often puzzles us as to whether to regard it as a true myelocyte. It is the meta-myelocyte of many authorities. (3) Between the mature or segmented polymorphonuclear and the immature one or metamyelocyte we have what may be designated the band-form nucleated one. These show the type of nucleus which one is familiar with in the nucleus of the transitional. (4) The mature, multilobed or segmented nucleus of the typical polymorphonuclear.
It would seem that if all tropical workers would agree upon some single method of recording differential counts it would be advantageous.
Under the blood findings in liver abscess, in a paragraph to follow in this chapter, I give suggestive counts indicating the value of Schilling-Torgau’s method.
In the differential count he not only divided up the polymorphonuclears but makes no separation of small from large lymphocytes. Although I have always divided lymphocytes into large and small ones I believe it unnecessary and unpractical and shall henceforth group all such cells in one grouping. The statement that large mononuclears and transitionals are cells of a similar origin, type and significance has always been my view.
Scheme of Schilling-Torgau
| Type of Cell | Normal Percentage |
Percentage Moderate Sepsis (W. C. 14,000) |
|
| 1. Mast cells | 1 | 1.0 | |
| 2. Eosinophiles | 3 | 1.5 | |
| { a. myelocytes | 0 | 0.5 | |
| 3. Neutrophiles | { b. immature forms (metamyelocytes) | 0 | 5.0 |
| { c. band-form (Stabkernige) | 4 | 13.5 | |
| { d. multilobed (Segmentkernige) | 63 | 64.0 | |
| 4. Lymphocytes | 23 | 10.5 | |
| 5. Large mononuclears and transitionals |
6 | 4.0 | |
Blood Culturing
Among tropical diseases, only malta fever, kala-azar and plague demand this method of diagnosis, although there are met commonly in the tropics many cosmopolitan diseases in which blood culturing is a principal diagnostic procedure. There are many ways of carrying out the cultivation of organisms from the blood but the one which may be strongly recommended is the following. The blood is obtained from a vein, the overlying skin of which has been painted with tincture of iodine to insure a sterile skin surface.
A stout hypodermic needle is attached to about 6 inches of rubber tubing which in turn is pushed over a downward bent glass tube which passes through a doubly perforated rubber stopper. A second glass tube, which also passes through the stopper, is bent upward to be attached to a second piece of rubber tubing for use in suction by the mouth. The glass tubes project about ½ inch below the under surface of the rubber stopper and above are about 2½ inches including the bent arm. This system of tubing and stopper is readily sterilized by boiling in a pan or instrument sterilizer. As a receptacle for the blood we employ Erlenmeyer flasks of 100 cc. capacity, containing 25 cc. of salt solution with 1% of sodium citrate, for prevention of coagulation. Blood that contains 0.2% of sodium citrate will not coagulate so that a 0.5% solution could be used instead of the usual 1% one. These citrated salt solution flasks are plugged with cotton, sterilized and kept on hand ready for immediate use, so that we only have to sterilize the stopper and tubing by boiling and flame the neck of the flask when removing the cotton plug to insert the stopper of the system. By suction we can take any amount of blood desired. I usually count the drops of blood as they fall into the citrated salt solution allowing 16 drops to the cc. In this way we may take from 10 to 25 cc. of blood at the bedside and then later on in the laboratory, when it is convenient, inoculate various media from the flask. For plates add 2 or 3 cc. of this citrated blood to 6 or 8 cc. of melted agar at 45°C. The blood mixture can also be added to various sugar bouillons for fermentation reactions. Finally we place the receiving flask in the incubator and culture it as well as the other media.
Clot Cultures.—A very simple method is to take blood with a Wright U-tube. Then centrifuge and use the serum for agglutination tests and the clot, emulsified in some liquid medium, for the blood culturing. For paratyphoid culturing bile media are preferable, just as for typhoid.
Lyon Blood Tube.—Quite recently I have been using the blood tube recommended by Lyon. To make it, heat a 5- or 6-inch section of ¼ inch tubing in the centre and draw out as for making 2 bacteriological pipettes. Divide and seal off the large end in the flame. Next seal off the capillary end. Then apply a very small flame to a point on the large end just before it begins to taper to the capillary part. The heat causes the heated sealed-off air inside to force out a blow hole. To use: Break off the sealed capillary end and allow the capillary end to suck up blood from a drop just as with the Wright tube. I consider this tube superior to the Wright one.
N. N. N. Medium.—In culturing blood for protozoa the N. N. N. medium is usually employed. Novy and MacNeal originally used a 12½% meat infusion containing 2½% agar, 2% peptone, 1% normal sodium carbonate solution and ½% salt. To one part of this agar, melted and cooled to 60°C., they added twice the amount of defibrinated rabbit’s blood. In the N. N. N. medium, as modified by Nicolle, there is beside the blood only salt and agar—no peptone or meat extractives.
Citrated salt solution was the medium used by Rogers in the cultivation of splenic juice from kala-azar patients.
The Taking of Blood for Serological Tests
This can be done with the Wright tube, pipetting off the clear serum after centrifuging. We usually draw blood from a vein by use of the system of stopper and tubing described under blood culturing but employing an empty, sterile centrifuge tube.
Agglutination Tests
There are two methods of testing the agglutinating powers of a serum—the microscopical and the macroscopical or sedimentation method.
For the microscopical method draw up serum to the mark 0.5 of the white pipette. Then draw up salt solution to the mark 11. This when mixed gives a dilution of 1 to 20. One loopful of the diluted serum and one loopful of a bouillon culture or salt solution suspension of the organism to be tested gives a dilution of 1 to 40. One loopful of the 1-20 diluted serum and 3 loopfuls of the bacterial suspension give a dilution of 1-80. These two dilutions answer in ordinary diagnostic tests. The red pipette with a 1-100 or 1-200 dilution may be used where dilutions approaching 1-1000 are desired. Having mixed the diluted serum and the bacterial suspension on a cover-glass, we invert it over a vaselined concave slide and examine with a high power dry objective (⅙ inch). It is simpler to make a ring of vaseline to fit the cover-glass and make the mixture of diluted serum and culture in the centre of this ring or square. Then apply the cover-glass, press it down on the vaseline ring and examine as with the ordinary hanging drop. In making dilutions it is preferable to use salt solution, as the phenomenon of agglutination requires the presence of salts. Ordinarily, thirty minutes is a sufficient time to wait before reporting the absence of agglutination. Agglutination is more rapid at body temperature than at room temperature. In reporting agglutination, always give time and dilution. It is absolutely necessary that a control preparation be prepared in every instance; that is, one with the bacterial culture alone or with a normal serum of the same dilution as the lowest used. Some normal sera will agglutinate in 1 to 10 dilution, and group agglutinations (as paratyphoid with typhoid serum) may occur in 1 to 40 or possibly higher. It is very unusual for sera to agglutinate any other bacteria then the specific one in dilutions as high as 1-80.
Macroscopic Agglutination.—For the macroscopical or sedimentation test, take a series of small tubes (⅜ × 3 inches) and deposit 1 cc. of salt solution in each of the series. Now, having taken an empty test-tube, drop 4 drops of serum in[518] it and then add 12 drops of salt solution. This approximately gives 1 cc. of a 1 to 4 dilution of the serum. It is more exact to make the 1 to 4 dilution with a graduated pipette. With a rubber-bulb capillary pipette, which has been graduated to hold 16 drops or 1 cc., draw up the contents of the tube containing the 1 to 4 serum and add it to the next tube containing 1 cc. of salt solution. This gives 2 cc. of a dilution of 1 to 8. Now mix thoroughly by drawing up and forcing out with the bulb pipette, and then withdraw 1 cc. and add to the next tube containing 1 cc. of salt solution. This gives a dilution of 1 to 16. Having mixed as before, again withdraw 1 cc. of the mixture and add it to the 1 cc. in the next tube. We now have a dilution of 1 to 32. Again withdrawing 1 cc. and adding it to the fourth tube containing 1 cc. of salt solution we have a dilution of 1 to 64. In tube 1 there is now 1 cc. of a dilution of the serum of 1 to 8; in tube 2, there is 1 cc. of a dilution of 1 to 16; in tube 3 of 1 to 32. Tube 4 contains 2 cc. of 1 to 64. The dilutions can be carried on in the same manner to any extent that may be desirable. In cholera agglutinations we may run up to 1 to 5000 or thereabouts. Of course, where such dilutions are employed, we generally start with 2 cc. of 1 to 50 in the first tube. When we have completed the series, each tube having 1 cc. of diluted serum, and the last 2 cc., we remove with the pipette 1 cc. from the last tube and discard it by ejection from the pipette leaving 1 cc. in the last tube. Now adding 1 cc. of a culture of typhoid or any other organism, we have the dilution of the serum in each tube doubled. Tube 1 now contains a serum in dilution of 1 to 16, acting on the bacteria; tube 2 of a 1 to 32; tube 3 of a 1 to 64. Now place these tubes in the incubator and, after two to five hours or overnight, we examine for the clearing up of the supernatant fluid. If the serum in a certain dilution agglutinates, the clumps gravitate to the bottom and the upper part becomes clear. If so desired, these dilutions may be carried on to 1 to several hundred in the same way. It is safer to work with dead cultures instead of living ones. To prepare, take a twenty-four-hour agar slant culture of typhoid or paratyphoid and emulsify in salt solution (about 6 cc. to a slant).
By adding 0.1 of 1% of formalin to the typhoid emulsion and placing in the ice-box the cultures will be found sterile in about three days. The emulsion should be shaken twice daily while undergoing sterilization in the ice-box. Such cultures are not easily contaminated and appear to retain their agglutinable qualities for several months. The macroscopic methods are preferable with such dead cultures. For our Dreyer emulsions we use a two-billion suspension of typhoid or para-typhoid organisms in 1 cc. of the formalinized culture.
Combination of Microscopical and Macroscopical Methods.—Microscopic: Prepare dilutions of serum as above described and take from each or several of the series, a loopful of the diluted serum. For control use a loopful of salt solution. Place on a cover-glass and add loopful of bouillon culture of the living organisms. Make hanging drop preparation, report after one hour at room temperature. Use ⅔ inch lens for examination.
Macroscopic: Add to each of the series, including the control, an equal amount of an emulsion of killed organisms.
The method of using a slide with two vaselined rings, one containing an emulsion in the specific serum and the other in salt solution, is of great practical value. This method is described under cholera.
Complement Fixation.—Complement fixation tests have been employed in the diagnosis of several tropical diseases but do not seem to be at present sufficiently reliable or practical with the exception of that for yaws and tularaemia. The chief difficulty with complement fixation tests for suspected sera is to obtain a reliable antigen. Should we later on be able to prepare bacterial antigens as satisfactory as Noguchi’s acetone-insoluble antigen is for the Wassermann test there may be a field for such tests in tropical pathology.
Other Practical Methods of Haematological Study
Haemoglobin Estimation
The standard method now is the estimation of the oxygen capacity of the blood, using some gas apparatus, such as Van Slyke’s. Otherwise, the most accurate instrument for this purpose is the Miescher modification of the v. Fleischl haemoglobinometer.

The apparatus is expensive, requires considerable time and care in the making of estimations, and is exclusively an instrument for a well-equipped laboratory.
Sahli’s Haemometer.—A simple and apparently very scientific instrument which has been recently introduced is the Sahli modification of the Gower haemoglobinometer. Instead of the tinted glass, or gelatin colored with picrocarmine to resemble a definite blood dilution, Sahli uses as a standard the same coloring matter as is present in the tube containing the blood. By acting on blood with 10 times its volume of N/10 HCl, haematin hydrochlorate is produced, which gives a brownish yellow color. In the standard tube, which is sealed, a dilution representing 1% of normal blood is used. To apply this test, pour in N/10 HCl to the mark 10 on the scale of the graduated tube. Add to this 20 cubic millimeters of the blood to be examined, drawn up by the capillary pipette provided. So soon as the mixture assumes a clear bright dark-brown color, which requires about ten minutes, add water drop by drop until the color of the tubes matches. The reading of the height of the aqueous dilution on the scale gives the Hb. reading. The tubes are encased in a vulcanite frame with rectangular apertures. This gives the same optical impression as would planoparallel glass sides.
The most accurate readings are obtained with artificial light in a dark room but almost as satisfactory comparisons can be obtained with natural light from a window. It is advisable to turn the ruled side around so that one may match colors without being influenced in his determination by the scale.
The apparatus must be kept in a dark place as strong light will change the color of the standard tube. It is recommended that the N/10 HCl be preserved with chloroform.
The Dare instrument is excellent.
Pappenheim has recently proposed an instrument in which the blood is converted into haematin hydrochloride as for the Sahli apparatus. Instead of matching a standard tube, with a dilution made drop by drop in the second tube, the new method employs a wedge-shaped glass vessel showing graduations of the brown colored blood, the treated blood being matched against the wedge-shaped container (Autenreith-Koenigsberger Haemocolorimeter).
Tallquist’s Haemoglobin Scale.—This is a small book of specially prepared filter-paper with a color-scale plate of ten shades of blood colors. These are so tinted as to match blood taken up on a piece of the filter-paper and are graded from 10 to 100. So soon as the blood on the filter-paper has lost its humid gloss, the comparison should be made. This is best done by shifting the blood-stained piece of filter-paper suddenly from one to the other of the holes cut in each shade—the piece of filter-paper being underneath the color plate. At least a square centimeter of the filter-paper should be stained by the blood. Daylight coming from a window to the rear or at the side should be used in making the comparison. The error with this method is probably not over 10% after a little experience. If the colored plate is not kept in the dark, the tints tend to fade.
Normal Blood
In considering what may be termed normal blood, it must be borne in mind that the normal varies for men, women, and children:
| Hb. | Red Cells | Leucocytes | ||
| Men, | 90 to 110%, | 5 to 5½ | million, | 7500. |
| Women, | 80 to 100%, | 4½ to 5 | million, | 7500. |
| Children, | 70 to 80%, | 4½ to 5 | million, | 9000. |
Color Index
This is obtained by dividing the percentage of the haemoglobin by the percentage of red cells, 5,000,000 red cells being considered as 100%.
To obtain the percentage of red cells it is only necessary to multiply the two extreme figures to the left by two. Thus if a count showed the presence of 1,700,000 red cells the percentage would be 34 (17 × 2 = 34). If the Hb. percentage in this case were 50, then the color index would be 50 ÷ 34, or 1.4.
In normal blood the color index is, approximately, 1.
In anaemias we have three types of color index: 1. The pernicious anaemia type which is above 1. Here we have a greater reduction in red cells than we have of the[521] haemoglobin content of each cell. For example, in a case of pernicious anaemia we have 2,000,000 red cells (40%) and 60% of haemoglobin, 60 ÷ 40 = 1.5. 2. The normal type, when both red cells and haemoglobin are proportionally decreased, as in anaemia fallowing haemorrhage. 3. The chlorotic type. Here there is a great decrease in haemoglobin percentage, but only a moderate decrease in the number of red cells. Hence the color index is only a fraction of 1. For example, in a case of chlorosis we have 40% of haemoglobin and 4,000,000 red cells, 40 ÷ 80 = 0.5.
One can judge fairly well the approximate color index by noting the character of the staining of the red cells. This is faint in bloods of low color index and deeper than normal in cells in a case with high color index.
Tests for Agglutination and Haemolysis of the Red Cells (Transfusion)
Transfusion of blood has become a method of greatest value in many types of anaemia.
In the selection of a donor for blood for transfusion it is always necessary to try his red cells against the serum of the recipient as well as the patient’s red cells against the serum of the donor, in order to prove the absence of haemolyzing or agglutinating bodies.
Certain persons have isohaemolysins in their blood which dissolve the red cells of other persons and in paroxysmal haemoglobinuria autohaemolysins may be present which can destroy the patient’s own red cells. This autohaemolysin seems operative only when a low temperature is followed by a high one. When haemoglobinaemia exists the liver converts it into bile pigment, causing bilious stools and jaundice. If one-sixth of the red cells are destroyed haemoglobinuria results.
In the following tables, two groupings of blood are given. Both are quoted in text-books, and both are in common use. Although that of Moss is more generally followed in France, England and the United States, the obvious desirability of having one classification universally employed, in order to avoid confusion and the possibility of serious accidents, has led to the recommendation that, on the basis of priority the grouping of Jansky be adopted.
In 1907, Jansky described the following four groups.
Group 1, the serum of which agglutinates the corpuscles of Groups 2, 3 and 4, while the cells are not agglutinated by any serum.
Group 2, the serum of which agglutinates the corpuscles of Groups 3 and 4, but not those of Groups 1 and 2, while the corpuscles are agglutinated by the serum of Groups 1 and 3, but not by those of Groups 2 and 4.
Group 3, the serum of which agglutinates the cells of Groups 2 and 4, but not those of Groups 1 and 3, while the corpuscles are agglutinated by the serum of Groups 1 and 2, but not by those of Groups 3 and 4.
Group 4, the serum of which does not agglutinate any corpuscles, while the corpuscles are agglutinated by the serum of all other groups.
In 1910, Moss made the following classification:
Group 1, the serum of which does not agglutinate any corpuscles, while the corpuscles are agglutinated by the serum of Groups 2, 3 and 4.
Group 2, the serum of which agglutinates the corpuscles of Groups 1 and 3, while the corpuscles are agglutinated by the serum of Groups 3 and 4.
Group 3, the serum of which agglutinates the corpuscles of Groups 1 and 2, while the corpuscles are agglutinated by the serum of Groups 2 and 4.
Group 4, the serum of which agglutinates the corpuscles of Groups 1, 2 and 3 while the corpuscles are not agglutinated by any serum.
At the present time it is accepted that the four groups considered include all adult persons; i.e., that the classification is complete.
Before transfusing carry out the following tests:
From a vein take about 1 cc. of blood in a centrifuge tube containing 1% of sod. citrate salt solution; then shift the stopper of the blood system to a dry centrifuge tube and draw into it about 3 or 4 cc. of blood. Throw down the citrated blood, pipette off the supernatant fluid and wash the sediment with normal saline.
Again pipette off the saline after centrifuging and make a 10% emulsion of the red-cell sediment in normal saline.
Centrifuge the coagulated blood in the other tube and collect the serum which separates from the clot.
Carry out these procedures for both donor and recipient.
Tests: 1. In a small test-tube deposit 1 drop of the donor’s 10% red-cell emulsion and then add 4 drops of the recipient’s serum.
2. Treat similarly 1 drop of the recipient’s red-cell emulsion with 4 drops of the donor’s serum.
3. Treat 1 drop of donor’s red-cell emulsion with 4 drops of his serum.
4. Treat 1 drop of recipient’s red-cell emulsion with 4 drops of his serum. Finally add 1 cc. of salt solution to each of the four tubes, shake gently and place in incubator for two hours.
5. Treat one drop of donor’s red-cell emulsion with four drops of salt solution.
6. Treat one drop of recipient’s red-cell emulsion with four drops of salt solution.
Tubes 5 and 6 are controls of saline.
Tests 3 and 4 should fail to show either agglutination or haemolysis. If agglutination or haemolysis appears in tubes 1 or 2, the donor is not satisfactory; but if agglutination appears in tube 2 only, he may be used in an emergency.
Some prefer to keep the tubes overnight in ice-box after the preliminary examination following incubation.
Lee’s Technique.—For the regular carrying out of this method one should keep on hand the sera of individuals belonging to groups 2 and 3 (Moss). To carry out the tests prepare a suspension of the donor’s red cells by dropping 2 or 3 drops of his blood into 1 cc. of citrated salt solution. Deposit a platinum loopful of standard serum 2 on a slide and emulsify in it a loopful of the donor’s red-cell suspension. A concave slide with two concavities is convenient, the serum-cell emulsion being made on the cover-glasses which are to be inverted over the vaseline ringed concavities. The agglutination can be observed with a high power magnifying glass or the[523] ⅔-inch objective. Agglutination, when it occurs, is usually complete in five to fifteen minutes. Repeat test with serum 3. If both test sera agglutinate the donor’s cells he belongs to group one. If neither agglutinate, to group four.
Agglutination by group two serum but not by three puts the donor in group three. Agglutination by group three serum but not by group two shows a group two donor. It would seem safe to use the cells of any donor of group 4, as such cells are not agglutinated by the sera of any group. It is, however, advisable to try to obtain a donor whose blood belongs to the same group as the donee. When standard sera 2 and 3 are not on hand one may use the following emergency method of Lee:
“A small amount of blood is collected from a patient (1 cc. from the ear or finger is sufficient), and allowed to clot. The serum is then obtained. One drop of this serum is placed on a slide and mixed with a drop of suspension of blood of the donor taken into 1.5% citrate solution. (A few drops of blood are taken into approximately 10 times the amount of 1.5 citrate solution and shaken. It is very important that the blood be dropped directly into the citrate, and should not be partially coagulated.) The test will appear in a few moments, and is best examined under the microscope, where, in the event of a positive test, marked agglutination will be evident. The test will also be evident macroscopically. In the event of a negative test it is a wise precaution to raise the cover-glass, and after making sure that the serum and cells are well mixed, to examine the preparation again. The only possible source of confusion is the appearance of rouleaux of the red corpuscle, indicating a too thick emulsion. If the test is negative, transfusion may be regarded as entirely safe.”
In the absence of agglutination haemolysis never occurs. Only about one-fifth of agglutinating sera prove also haemolytic. Rarely a pernicious anaemia patient’s serum may agglutinate his own red cells. This auto-agglutination is regarded as an important test in acquired haemolytic jaundice.
Occult Blood
When the presence of blood in the faeces, gastric contents, urine or body fluids, is suspected but cannot be recognized by macroscopic or microscopic methods, it is necessary to resort to spectroscopic or chemical tests. These tests are, however, individually unsatisfactory. The spectroscopic method is not delicate, the haemin-crystal method does not give uniform results and the various color tests, although very sensitive, are given by many substances other than blood. Consequently, it may be said that, with the color tests, it is negative results that are significant, and with other than the color tests it is positive findings that are informative. Serological tests are the most satisfactory medicolegally.
Haemin Crystal Test (Teichmann).—Prepare a solution (stable) of 0.1 gm. each of KI, KBr, and KCl in 100 cc. acetic acid. Mix a few drops with some of the material on a slide, apply a cover-glass, and gently warm until bubbles begin to appear. Then cool slowly, and examine for the characteristic dark-brown crystals.
Haemochromogen Crystals (Donogány).—Mix one drop each of suspected fluid, pyridin, and 20% NaOH on slide, and let dry. If positive, radiating needles will form after several hours.
Spectroscopic Tests.—These depend upon the recognition of the characteristic absorption spectra of haemoglobin or its derivatives (Fig. 24). The degree of concentration influences their appearance, and one should start with a relatively concentrated solution, diluting cautiously until the bands are typical.
The small, direct-vision (hand) spectroscope suffices. A wavelength scale is a convenient attachment. Daylight or strong artificial light (such as the “daylite” lamp) is used. Have solution in a small test tube or, preferably, a flat cell with a thickness of about 1 cm. Before use, focus Frauenhofer’s lines sharply.
Reducing agents are employed, such as ammonium sulphide, or Stokes’ solution made up as follows: Dissolve 3 gm. FeSO4 in cold H2O; add cold, aqueous solution of 2 gm. tartaric acid; make up to 100 cc.; immediately before use, add strong NH4OH until precipitate first formed is dissolved. Both solutions must be freshly prepared, and the sulphide must be warmed to about 50°C.
Material that is uncontaminated, relatively fresh and in relatively concentrated aqueous solution may give any or all of the upper three spectra, a few drops of reducer changing the first to the second.
If the material is older, dissolve the suspected stain in 1-2 cc. of 10% NaOH, heat almost to boiling, cool, and add a few drops of reducer. Examination shows Spectrum 5.
It is better, however, especially with much contamination, to prepare an ethereal, acid extract. After having ground the material thoroughly with water, if it is not already in liquid form, shake it with an equal volume of neutral ether. Reject ether extract, and, to 10 cc. of residue, add 3 to 5 cc. of glacial acetic acid. Shake thoroughly with an equal volume of ether. If the ether does not separate readily, mix gently with a few drops of alcohol. Remove ethereal extract, and evaporate it to a small bulk for use in tests. Examination will show spectrum of acid haematin, which, however, in ethereal solution, resembles Spectrum 3 more than 4.
Donogány’s Method increases the delicacy of the spectroscopic test, and is also a color test. Dissolve the pigment with 20% NaOH, add fresh pyridin and, if necessary, fresh ammonium sulphide. Filter. The filtrate will be more or less orange-red according to blood content, and will show Spectrum 5.
Color Tests.—The reliability of these may be enhanced by the use of methods which involve the removal or destruction of interfering substances. In such a method, the original aqueous solution is boiled for 15 to 20 seconds, and the acid ethereal extract is prepared as previously described. This extract is dropped on filter-paper, the reagents being applied to the moistened spot. The delicacy of these several tests is variable, being greater with blood in aqueous solution than in biological fluids, but it may be given as approximately 1-25,000 for the guaiac and aloin, and 1-250,000 for the benzidine test.
(a) Treat moist spot with a few drops of freshly prepared 2% alcoholic solution of guaiac resin, and then a few drops of hydrogen peroxide. A blue color is “positive.”
(b) Treat moist spot with a few drops of 3% aloin in 70% alcohol, and then with ozonized turpentine (turpentine that has stood for a few days in an open vessel in sunlight). A purplish-red color within 10 minutes is “positive.”
(c) Treat moist spot with 2 drops of glacial acetic acid, a few crystals of benzidine (preferably white), and finally 2 drops of hydrogen peroxide. A greenish-blue color is “positive.”
Acidosis
Everyone is familiar with that form of respiratory disturbance associated with diabetic coma that is known as Kussmaul’s air hunger. Here we have hyperpnoea, a form of dyspnoea typically without cyanosis, and furnishing the best clinical evidence of acidosis. Acidosis, however, is now recognized to be but a particular phase of disturbance of the acid-base equilibrium of the body, and recent work has radically changed our conceptions of its features and its intricate relationships.
Van Slyke restricts the use of the term “acidosis” to describe a condition caused by acid retention sufficient to lower either the bicarbonate or the pH of the blood below normal limits. The pH of the blood may be considered the danger sentinel; as long as it is normal, the acid-base equilibrium is normal or compensated; otherwise, it is uncompensated, and life is seriously threatened. The normal pH of the blood may be given as 7.3 to 7.5 (a slightly alkaline reaction), each individual, however, probably having normally narrower limits of variation. That of the blood serum is about 0.2 pH higher, and that of the other body fluids (not the excretions) probably closely approximates and promptly follows any change in that of the blood plasma. Variations to the acid side may, for a short time at least, be as low as 7.0, although not much lower without fatal results; 7.0 is considered the point where coma occurs. Variations to the alkaline side (Alkalosis) beyond 7.8 are accompanied by symptoms of tetany, although one is not at present justified in assuming that all tetany is either caused, or accompanied, by alkalosis. So, the extreme range of reaction compatible with life probably lies approximately between pH of 7.0 and 7.8.
Recent, but as yet unconfirmed, work suggests that the severe reactions following intravenous medication or infusions may be due, at least in part, to the fact that the pH of the fluid introduced is decidedly more acid or alkaline than that of the blood. This applies to solutions of glucose, the salines, and possibly also to sodium citrate, arsphenamine, sera, antitoxins, etc. The question of suitably buffering such solutions, e.g., with suitable phosphate mixtures, in order to avoid disturbance of the acid-base equilibrium, is being studied, and the preliminary results are promising.
The hydrogen-ion concentration (or its derivative, pH) of the blood varies as the ratio between the concentrations of dissolved carbonic acid and bicarbonate (generally indicated by (H2CO3)/(NaHCO3)), i.e., a relative increase in the H2CO3 increases the hydrogen-ion concentration and lowers the pH, and vice versa. The stability of this ratio is preserved by body mechanisms operative in controlling its two factors,—the H2CO3 being under respiratory control, and the NaHCO3, considered as representing the alkali reserve, being normally maintained by food.
The erythrocytes control the concentration of bicarbonate by virtue of their haemoglobin and the reversible reaction.
H2CO3 + NaCl ⮂ HCl + NaHCO3
The HCl passes into the cell, and is probably held by the haemoglobin. In the lungs, the CO2 is excreted and NaCl reformed. This ability of haemoglobin to form bicarbonate is important inasmuch as the corpuscles can conceal 5 to 10 times as much acid as the plasma bicarbonate can ordinarily neutralize. A full appreciation of the significance of this ratio being the basis of an intelligent comprehension of acid-base equilibrium, a detailed analysis of factors that tend to influence the ratio is given.
Factors Operating:
- A. To increase or protect bicarbonates:
- 1. Administration of bicarbonate.
- 2. Loss of gastric HCl induced by obstructing the pylorus, and regularly washing out the stomach for some days.
- 3. Processes indicated by increased excretion in the urine of ammonia compounds, the ammonia being probably diverted from urea formation, and of substances producing a titrable acidity, they including buffer acids such as acid phosphates.
- 4. Possibly a shift of HCl to the tissue cells from the plasma like that from the plasma to blood cells.
- B. To decrease bicarbonate:
- 5. Acid substances, by their
- (a) Increased production.
- (b) Decreased elimination or
- (c) Ingestion.
- 6. Diuresis, with elimination via the urine.
- 7. Lack of Factor A (3).
- 8. The hyperpnoea associated with deficient oxygen.
- C. To increase carbonic acid:
- 9. Administration of carbonic acid.
- 10. Impaired diffusion in the alveoli of the lungs.
- 11. Slowing of respiration.
- D. To decrease carbonic acid:
- 12. Hyperpnoea.
- (a) Voluntary.
- (b) Due to disease processes.
- (c) Due to low oxygen content of air.
- (d) Emergence from warm water.
- 13. Low atmospheric content of CO2.

Figure 152 is a graphic representation of essential facts in acid-base equilibrium. Ordinates represent total CO2 content, which comprises that in simple solution and that as bicarbonate of whole blood in volumes per cent, and abscissae the mm. CO2 tension in the blood as drawn. The line OT gives the proportion of total CO2 present in simple solution. pH values are shown by the lines OL, OM, etc. The extreme normals for carbon dioxide absorption curves are OP and OR. The CO2 tension of alveolar air may be the same or vary as much as 20 mm. below, while that of venous blood will be about 6 (0.8-10.0) mm. higher than that of arterial blood. The “CO2 capacity” (or “CO2 combining power”) of plasma may be as much as 15 vol. % more than the total CO2 of whole blood.
The actual state of acid-base balance, then, can only be determined by the use of any two of a number of interdependent variables, such as total CO2, CO2 tension, pH, H2CO3 concentration, other buffers than bicarbonate, plasma chloride, ratio of oxyhaemoglobin to haemoglobin, etc. Findings that fall within ABCD and at about 40 mm. tension indicate a normal equilibrium for the resting individual at ordinary altitudes. Or, such a normal would be a total CO2 of about 49 (43-56) vol. % for whole blood, and 50-65 vol. % for plasma. The normal for the individual falls within narrower limits.
If either H2CO3 or bicarbonate varies from normal values, there is apparently an effort on the part of the body to compensate by adjusting the other so as at least to maintain a normal pH. This is accomplished by respiration, or by diverting alkali from or recalling it to the blood stream. Naturally, treatment of any such abnormal condition will do well to imitate Nature’s efforts. Haggard and Henderson have demonstrated that blood alkali may be decreased in two ways—by acids (the acidotic process) or by acapnia (the acapnial process). By the forced breathing of the acapnial process the lungs are over-ventilated and an excessive amount of carbon dioxide is washed out of the blood, thus bringing on a temporary alkalosis. In case of prolonged forced breathing, nature prevents an extreme alkalosis by causing the alkali to leave the blood, it being stored in the tissues or excreted in the urine. Blood relatively poor in carbonic acid or relatively rich in alkali acts to depress respiration, and the slowing of respiration produces an acidosis by the resultant retention of H2CO3, this causing alkali to be recalled from the tissues. Thus acidosis, in calling more alkali into the blood from the tissues, represents what may be regarded as a restorative effort. Hence, administration of bicarbonate is indicated in acidotic processes, and of CO2 in acapnial; the use of the wrong one is dangerous.
The numbered regions of the chart are associated with various clinical conditions, e.g., tetany from 1, 2, and 3; the acidosis of diabetes mellitus, nephritis, or infantile marasmus with 6 or 9; pneumonia, morphine narcosis, and breathing of air containing 3-5% CO2 with 7 or 8; emphysema with 4; some cardiac cases with 9; overdose of bicarbonate with 1 or 4; fever with 2; as the result of high altitudes, 2 or 3, or, when acclimated, 6; shock (handling of intestines), deep ether anesthesia, and carbon monoxide asphyxia with lowered bicarbonate. The disturbances of acid-base equilibrium in the last two are the result of acapnial processes.
Normal metabolism results in the constant formation of acids, especially H2CO3, and disease processes may occasion the presence of still more. A constant loss of alkali results, the neutralization products being eliminated mostly in the urine, and the H2CO3 via the lungs; the body fluids are excellently buffered, the most important buffers being bicarbonate, proteins (especially haemoglobin), and phosphates. In the maintainance of the normal pH, the CO2 (or H2CO3) is the easily variable factor. The onslaught of invading acids is first met by the bicarbonates (acidotic process); hyperpnoea lowers the H2CO3 and a normal pH is maintained until the bicarbonates are reduced to one-fourth (perhaps even to one-eighth) of their normal concentration. If, nevertheless, the pH falls (and only then), the other buffers are used, and, if it reaches 7.0, most of the remaining bicarbonate becomes available. The blood handles the situation, but buffers from the tissues or other body fluids also become available in extreme cases.
As noted above, measurement of one variable will be inadequate exactly to determine the state of acid-base equilibrium. As long, however, as the pH is normal, which is the usual finding in most pathological conditions, including mild acidosis, one determination will suffice. Clinical methods comprise tests for whole blood or plasma CO2 or bicarbonate, alveolar CO2 tension, bicarbonate tolerance, pH of blood or urine, Sellard’s test, NH3 quotient of urine, or presence of abnormal acids (particularly acetone bodies) in blood or urine. The first two methods are the ones of choice, particularly the first, as, by it, one can estimate the reserve of the very important blood buffer, bicarbonate, and its result closely indicates the total buffers.
The tolerance for bicarbonate is a very convenient and practical measure of acidosis, and means the dose of NaHCO3 required to produce a urine alkaline or amphoteric to litmus. A normal finding is 5-10 grams; 20 is required with a mild, 30-40 with a more severe, and more than 40 gm. with extreme degrees of acidosis. In coma, it is usually impossible to produce an alkaline urine.
Certain changes in the urine are recognized and acceptable as indirect evidence of acidosis, but these changes are not synonymous with acidosis, being dependent in part upon renal integrity and other factors. The NH3 quotient of urine (ammonia nitrogen; total nitrogen), as usually determined with patient on a mixed diet, is normally about 5%. Values of 10-40% occur in acidosis. It may be increased by diet, disturbances of protein metabolism, ammoniacal fermentation, etc., and there may be no increase in certain diseases with acidosis. The ammonia probably does protect the blood alkali, but its efficacy is intimately associated with renal function, inasmuch as Nash and Benedict have presented strong evidence to the effect that urinary and blood NH3 is the product of an active synthetic function of the kidneys themselves. Acetone bodies in the urine (ketonuria), in the blood (ketosis), or in the breath, have diagnostic value but are poor indices of severity of acidosis and may be absent in acidosis. Acetone and diacetic acid have the same significance: a progressive increase gives a grave prognosis, and it is generally considered that the presence of β-hydroxybutyric acid indicates greater severity.
Acidotic acidosis is due either to the abnormal formation or ingestion of acid substances, or to decreased elimination of normal metabolic products. Ketosis is the important example of the former, and retention of acid phosphates of the latter. In either case, the body is robbed of its bases. The acidosis of diabetes mellitus is characterized by ketosis and increased NH3 quotient of urine, while that of nephritis is a phosphate retention without ketosis, and, as one would expect, the NH3 quotient is usually not increased. Infantile diarrhoea with ileocolitis shows a marked ketosis, but, lacking the ileocolitis, the ketosis is only moderate and the acidosis is due to phosphate retention.
The appearance of an acidosis in disease constitutes a serious development demanding immediate attention. It is usually present at time of death and may be the immediate cause. We must be prepared for the appearance of acidosis in the course of numerous cosmopolitan diseases, and its presence has been recognized in a few tropical conditions. Before we generally recognized the great importance of the acidosis factor in pathology, there were two standard treatments for yellow fever and blackwater fever, the Sternberg one in the former and the Hearsey one for the latter, both of which had as a basis the administration of alkalis, which is our best means for neutralizing the deleterious action of increased acid production in the body or defective elimination of the same. It was a very important contribution to the[530] therapeutics of cholera when Sellards, recognizing the tendency of the nephritis to produce an acidosis in this disease, made use of intravenous injections of NaHCO3 to combat the condition, thus counteracting the anuria, one of the chief complications leading to death. More recently, the Egyptian workers noted an acidosis in kala-azar, a finding verified and emphasized by Rogers. There is also an acidosis in heat stroke, so that intravenous or rectal injections of NaHCO3 are of value. It will thus be seen that acidosis is a most important condition to keep in mind in tropical conditions, and it will be well to be on the watch for other varieties of disturbance of acid-base equilibrium.
Relative to the administration of bicarbonate in treatment, there is now a decided reaction against the use of amounts that may prove injurious by reason of the danger of alkalosis. There is a tendency to employ it only in decompensated acidosis, and control it by estimations of plasma CO2 capacity, 0.5 gm. NaHCO3 per 19 kg. body weight will raise the plasma CO2 capacity by 1 vol %. It is distinctly contraindicated in cases whose low plasma CO2 is due to acapnial processes. Early administration is desirable in children, and good results are obtained, especially with the older ones. An acidosis, however, once established in infants may cause death despite alkali. In order to avoid over-dosage of bicarbonate, methyl red, which is more sensitive than litmus to early changes in the reaction of the urine, should be employed as an indicator. The appearance of a yellow color upon its addition to the urine is the sign to suspend further administration of alkali.
Glucose is indicated in conditions with ketosis due to carbohydrate deficiency, providing the organism can assimilate it.
Chemical Analysis of Blood
The chemical analysis of the blood has attained a clinical simplicity and significance that demands recognition. It provides points of value in diagnosis, prognosis, and treatment, being especially useful in nephritis, diabetes, acidosis, comatose conditions, gout, and in questions of renal function and treatment, especially dietetic. Urine findings are always dependent upon kidney function, and, by blood chemistry, we can pass behind this barrier.
Few diseases have been as yet studied thoroughly in this respect, but our fund of knowledge is receiving constant additions. The field of tropical medicine is practically untouched, and it is quite possible that an investigation along this line might there yield facts of interest and value.
The following table (amplified from Myers), is a concise summary of normal findings and those encountered in various clinical conditions. The diagnostic significance is evident. Some of the results are based upon the analysis of many cases; others upon but few. One might include the findings mentioned elsewhere regarding acidosis in certain tropical diseases, but, except for such, we have no other data relative to them, unless one mentions that blood sugar is increased in the tropics. The values are given in milligrams per 100 cc. whole blood (the usual system), except those for diastatic activity (recorded in Winslow’s empirical units) and acidosis (expressed in terms of plasma carbon dioxide combining power—volumes %). “Inc.” and “Dec.” signify increased and decreased respectively.
Result of Chemical Examination of Blood
| Condition | Non protein nitrogen |
Urea nitrogen |
Uric acid |
Creat- inine |
Sugar | Chole- sterin |
Chlor- ides |
Dias- tase |
Plasma CO2 capacity |
| Normal | 25-300 | 10-15 | 2-3 | 1-2 | 90-120 | 170-250 | 450-500 | 8-64 | 53-77 |
| Diabetes mellitus, mild | .. | .. | .. | .. | 150-300 | .. | .. | Inc. | .. |
| Diabetes mellitus, severe | .. | 20 | 4-10 | 2-4 | 300-1200 | Inc. | Dec. | Inc. | 10-50 |
| Nephritis, acute | .. | 40-100 | 5-15 | 2-6 | 120-180 | .. | Inc. | .. | 20-45 |
| Nephritis,interstitial, early | .. | 15-25 | 5-12 | 2-3.5 | 120-150 | .. | .. | Inc. | .. |
| Nephritis, interstitial, terminal | 100-300 | 60-300 | 5-27 | 5-28 | 120-240 | Inc. | Variable | Inc. | 12-40 |
| Nephritis, parenchymatous (nephrosis) | .. | 20-50 | 2-5 | 2-4 | 120-200 | Inc. | Inc. | .. | .. |
| Nephritis, chronic diffuse, severe | .. | to 230 | to 10 | to 16 | to 250 | .. | .. | .. | .. |
| Uraemia | 90-350 | 70-300 | .. | .. | .. | .. | .. | .. | .. |
| Kidney polycystic, double | .. | to 75 | to 5 | to 8 | to 200 | .. | .. | .. | .. |
| Prostatic obstruction | Inc. | 12-40 | 3-9 | 1.5-3.5 | 110-160 | .. | .. | .. | .. |
| Gout | .. | .. | 4-10 | .. | .. | .. | .. | .. | .. |
| Hyperthyroidism | .. | Inc. | .. | .. | Inc. | .. | .. | Inc. | .. |
| Hypoendocrine conditions | .. | Dec. | .. | .. | 60-90 | .. | Dec. | Dec. | .. |
| Eclampsia | 25-45 | 10-25 | 4-8 | .. | .. | .. | .. | .. | 43-58 |
| Intestinal obstruction, acute | 75-170 | 45-120 | Inc. | Inc. | .. | .. | .. | .. | .. |
| Fever, acute | .. | Inc. | Inc. | to 4 | .. | Dec. | Dec. | .. | .. |
| Pneumonia, severe and late | .. | to 53 | to 18 | to 3.5 | to 180 | Inc. | Dec. | .. | Dec. |
| Anaemia, pernicious | to 108 | to 75 | to 10 | to 3.1 | to 300 | Dec. | Inc. | .. | Dec. |
| Malignancy, late | Inc. | Inc. | Inc. | Inc. | .. | Dec. | Inc. | .. | Dec. |
| Dementia praecox, catatonic | .. | 6-10 | Dec. | .. | Inc. | .. | .. | .. | .. |
| Shock | Inc. | Inc. | .. | Inc. | Inc. | .. | .. | .. | Dec. |
| Bichloride of mercury poisoning | to 370 | to 300 | to 15 | to 33 | 120-200 | Inc. | .. | .. | .. |
| Plumbism | Inc. | Inc. | Inc. | .. | .. | .. | .. | .. | .. |
Interstitial nephritis is characterized by a nitrogen retention, while parenchymatous nephritis has relatively little nitrogen retention but does have a decided tendency towards chloride retention. Essential hypertonia with its normal blood chemistry is differentiated from arteriosclerosis with its frequent nitrogen retention. The imminence of uraemia may be judged by the extent of the nitrogen retention. We have an aid in the differentiation of the uraemia of nephritis accompanied by a flagging heart from the passive congestion of cardiac decompensation, especially as to which is the secondary condition, and thus therapeutic indications relative to mooted questions of treatment (hot packs, morphine, renal stimulants, etc.). Unsuspected cases of nephritis showing only gastric symptoms clinically have been detected by blood chemistry. The significance of albumin in traces and occasional casts in urine has been more definitely established by examination for increase of uric acid in the blood—an increase arguing for an organic lesion. Values of over 4 for creatinine do not occur without great impairment of renal function, and findings of more than 5 have practically uniformly foretold a fatal termination in less than six months, except in acute nephritis and mild bichloride of mercury poisoning. The creatinine is also the best guide to the status of renal function in terminal cases. The chloride and nitrogen content afford guides to diet.
The blood may indicate a prediabetic state, and place the practitioner upon his guard. There is a condition but recently recognized in which there is a normal blood sugar, a persistent glycuresis of usually less than 1% and independent of carbohydrate intake, occasionally polyuria, but with no other symptoms of diabetes mellitus. It is known as renal diabetes, is apparently harmless, probably not uncommon, and may represent the condition affecting most of those “diabetics” who can disregard diet with impunity. The blood sugar and plasma CO2 are usually considered the only safe guides in the treatment of diabetes mellitus and no extended medical treatment or surgical interference should ever be attempted without their estimation. Glycosuria is a poor guide, especially in advanced cases.
In comatose conditions, nitrogen retention will indicate the uraemic, and hyperglycaemia the diabetic cases. But acute nephritis should always be borne in mind, as it may have a pronounced acidosis but no nitrogen retention.
A high uric acid finding alone is characteristic of gout, and aids in differential diagnosis from simple rheumatic fever and other arthritides, any uric acid retention in them being usually accompanied by retention of other nitrogenous elements. It is especially useful in the diagnosis of gouty arthritis without tophi.
The efficacy of treatment will, in general, be shown by the degree of approach to normal blood findings.
Leucopenia
This is a term used to designate a reduction in the normal number of leucocytes. A leucocyte count of 5000 would represent a slight leucopenia; one of 2000, a marked leucopenia. In the later stages of typhoid, and in acute miliary tuberculosis, we expect a moderate leucopenia. Glandular tuberculosis may give a very marked leucopenia. Tuberculous peritonitis will show moderate leucopenia or a normal count.
The leucopenia of typhoid is moderate and is often preceded in the first few days by a moderate neutrophile leucocytosis. Later on we have a decided increase in the lymphocytes. A marked diminution or absence of eosinophiles is so characteristic that any increase in eosinophilic percentage negatives a diagnosis of typhoid.
Paratyphoid gives a similar blood picture.
Chronic alcoholism and chronic arsenic poisoning cause a reduction in the number of the white cells. Pernicious anaemia, especially the aplastic type, shows a marked leucopenia, as is also the case with Banti’s disease. Two tropical diseases, kala-azar and dengue, show a marked leucopenia, the counts often being below 2500. During the apyrexial period of malaria we may have a white count of 5000.
It has recently been claimed that a leucopenia with a coincident marked reduction in the lymphocytes is characteristic of measles and that this occurs several days before the Koplik spots appear.
Kocher notes that in exophthalmic goiter the leucocyte count is considerably diminished and that the polymorphonuclears are not much more than one-half the usual percentage while the percentage of the lymphocytes is almost double the normal.
X-ray treatment tends to destroy leucocytes in the exposed region, especially polymorphonuclears. The small lymphocytes are least affected.
Eosinophilia
Where the eosinophiles are increased to 5%, we have a moderate eosinophilia. In some cases of infection with intestinal parasites, especially hookworms, but also from other parasites, as round and whip-worms, we may have an eosinophilia of 30 to 50%. In Guam, among the natives, it is difficult to find an eosinophile count under 15%. The eosinophilia tends to disappear when the anaemia becomes very severe.
Echinococcus infection has an eosinophilia which disappears when the cyst is removed. Continuance of the eosinophilia indicates that all cysts were not gotten rid of.
The eosinophilia of trichinosis is best known, and a combination of this blood finding with fever and marked pains of muscles, would justify the excision of a piece of muscle for examination for encysted embryos.
In true asthma eosinophilia is marked, and its absence is of value in indicating other causes for the condition. Certain skin diseases, especially pemphigus, show eosinophilia. Blastomycoses are usually found to show eosinophile increase.
An increase of eosinophiles always attracts attention to the possibility of intestinal parasite infections or to skin affections. The explanation of eosinophilia is obscure although Neisser regards the increased production of eosinophiles as an expression of sympathetic system irritation.
Eczema and psoriasis are not apt to give more than 3 or 4% eosinophiles. A rather high degree of eosinophilia is found in mycosis fungoides.
Scabies also gives an eosinophilia.
The proportion of eosinophiles in the blood of children is greater than in that of adults.
Increase of both eosinophiles and mast cells is found in myelogenous leucaemia.
An eosinophilia tends to appear following splenectomy. With a Wright stain showing acid tendencies one may count polymorphonuclears as eosinophiles unless noting smaller size of granules.
Leucocytosis
It is to an increase in the polymorphonuclears that this term is usually applied, the term lymphocytosis or eosinophilia being employed where white cells of eosinophile or lymphocyte nature are increased. We have physiological leucocytosis in the latter weeks of pregnancy, also in the new-born, and in connection with digestion.
Pathological Leucocytosis.—Pneumonia. In this disease we have a leucocytosis of 20,000 to 30,000 or higher. The eosinophiles are almost absent. A normal leucocyte count in pneumonia makes a prognosis unfavorable.
The leucocyte count drops about the time of the crisis, and with the reappearance of eosinophiles is a favorable sign.
Toxaemic conditions as uraemia, diabetic coma and poisoning by CO2 tend to show a leucocytosis.
Septic processes. The leucocyte count is of great value, especially when we obtain a leucocytosis with 80 to 90% of polymorphonuclears, as in appendicitis, cholecystitis, or other suppurative conditions.[535] A marked leucocytosis is of diagnostic importance in acute ulcerative endocarditis provided it is not fulminant in type.
According to Cabot, leucocytosis varies in infections as follows:
1. Severe infection—good resistance; early, marked and persistent leucocytosis.
2. Slight infection—slight resistance; leucocytosis present, but not marked.
3. In fulminating infections we may have no increase in whites, but a higher percentage of polymorphonuclears.
4. Slight infection and good resistance may not be productive of leucocytosis.
It is in connection with the question of operation in appendicitis or similar conditions that the matter of a leucocyte count is of prime importance. If there be a leucocytosis but with less than 75% of polymorphonuclears it indicates an infection of little virulence or a walled-off process with an exacerbation. It is difficult to form an opinion when the polymorphonuclears are under 80%. Leucocytosis with polymorphonuclear percentage of 85 to 90 indicates immediate operation; percentages over 90 point to peritonitis and if with such percentages of polymorphonuclears there is absence of leucocytosis the prognosis is grave.
The blood of cases with malignant tumors tends to show a moderate leucocytosis except in epithelioma of the skin. When a cancer is ulcerating quite a high white count may be obtained.
Spirochaete fevers, as relapsing fever, may give a leucocytosis of from 25,000 to 50,000.
Smallpox, especially at time of pustulation, plague, scarlet fever, and liver abscess give a leucocytosis of from 12,000 to 15,000.
Smallpox often shows a very large percentage of very characteristic large mononuclears.
The leucopenia and lymphocyte increase in measles are important points in differentiating it from scarlatina.
Influenza shows a leucopenia at first, then a leucocytosis and, following the fall in fever, a second lowering. The very fatal pneumonias of the 1918 epidemic of influenza showed a marked leucopenia.
With meningitis counts of 25,000 are not unusual, in abscess of the brain the white count rarely exceeds 15,000.
Poliomyelitis and polioencephalitis give a slight leucocytosis during the febrile accession.
Erysipelas and epidemic cerebro-spinal meningitis also give a leucocytosis of from 15,000 to 20,000. In malignant diseases we sometimes have a moderate leucocytosis. Rogers states that in liver abscess, with a leucocytosis of 15,000 to 20,000 we have only about 75 to 77% of polymorphonuclears—there being also a moderate increase in the percentage of large mononuclears.
Drugs such as antipyrin may give a leucocytosis. The leucocyte increase of pilocarpine is rather a lymphocytosis. Cinnamate of soda, sodium nucleate, bacterin injections and turpentine have been used in kala-azar to increase leucocytes.
Lymphocytosis
Of course, the disease in which we have the most marked lymphocytosis is lymphatic leucaemia.
The lymphocytosis of typhoid fever has been taken up under leucopenia.
Whooping-cough may give a lymphocytosis of 20,000 to 30,000.
Young children have normally an excessive proportion of lymphocytes even to a reversal of the polymorphonuclear-lymphocyte relation of adults. This is apt to be particularly marked in hereditary syphilis. Enlarged tonsils may give rise to lymphocytosis of 10,000 to 15,000 when more than 50% of the white cells will be lymphocytes. Rickets and scurvy give a lymphocytosis.
In pellagra there is a moderate lymphocytosis, averaging 34% in about a normal count.
Varicella and mumps may also give an increase in the percentage of lymphocytes.
Malta fever is a disease which may show quite a lymphocyte increase, this going with a reduction in polymorphonuclears.
Glandular fever (Pfeiffer, 1889) is a mild acute febrile disease, the fever coming on after a short incubation period and lasting about one week. Its main characteristics,—soft enlargement of the lymphatic glands, splenomegaly, and a leucocytosis of about 20,000 with 80% lymphocytes of the lymphoblastic type and many with bilobed Rieder nuclei,—lead often to its being mistaken for lymphatic leucaemia. Throat infections, particularly Vincent’s spirillosis, are thought by some to be concerned in its genesis.
Increased Large Mononuclears
In tropical work we combine the large mononuclears and transitionals in a differential count. They are the phagocytes of animal cells or parasites. The disease in which their increase is best recognized is malaria and an increase to 15% where the blood shows moderate leucopenia is very significant. The melaniferous leucocytes of malaria are cells of this type.
Other protozoal infections, as kala-azar, trypanosomiasis and amoebiasis cause it. Filterable-virus diseases may show a mononuclear increase, thus yellow fever and dengue both give an increase about the fifth or sixth day.
In Banti’s disease there is an increase in cells of this type and a transitional increase is reported for Hodgkin’s disease.
Diseases in Which There is a Normal Leucocyte Count
Uncomplicated tuberculosis, influenza, Malta fever, measles, trypanosomiasis, malaria, syphilis, and chlorosis.
In malaria we have a leucocytosis at the time of the rigor, while during the apyrexial period there is a moderate leucopenia. In malaria we have a marked increase in the percentage of the large mononuclears and transitionals. These may form from 20% to 30% of the leucocytes. When bearing particles of pigment they are known as melaniferous leucocytes—macrophages which have ingested malarial material. In dengue, at the time of the terminal rash, we may have as great a percentage of large mononuclears. In this disease, however, we have a great diminution of polymorphonuclears from the start (25 to 40%). Instead of a large mononuclear we have at the onset a lymphocytic increase. There is an increase of large mononuclears in trypanosomiasis.
The white count is about normal in uncinariasis (Ashford’s average was 7800). Some have reported a leucopenia in severe cases.
While eosinophilia is the most marked feature in hookworm disease yet in very severe cases it may be absent.
Coagulation Rate of Blood
This determination is of value in connection with operations on jaundiced patients.
Wright’s coagulometer is a standard instrument but is cumbersome.
A simple method of determining the rate is to take a piece of capillary glass tubing and hold it downward from the puncture to let it fill for 3 or 4 inches. Then at intervals of thirty seconds scratch with a file the capillary tubing at short distances and break off between the fingers. When coagulation has taken place a long worm-like coagulum is obtained. Normally coagulation occurs in about three to four minutes, when the temperature is that of the hand in which the tubes are conveniently held. Rudolf recommends placing the tubes in metal tube-containers in a Thermos bottle at 20°C. He gives the normal coagulation rate for this temperature as eight minutes, while at a temperature below this the period is lengthened. Age and sex do not influence the rate. Sabrazes, the originator of this method found no appreciable variation in tubes from 0.8 to 1.2 mm diameter.
In Burker’s test you mix a drop of blood in a drop of distilled water on a slide and with a capillary tube sealed off at the end stir the mixture every half minute. So soon as fibrin threads appear you have coagulation.
For the proper testing for coagulation rate the blood should be taken from vein and not from that exuding from a needle stab of ear or finger. Our experience shows that it is not necessary to use venous blood.
Specific Gravity of the Blood
Hammerschlag has a method for the determination of the Hb. percentage based upon the specific gravity of the blood.
In this method a mixture of benzol and chloroform is made of a specific gravity of about 1050. A medium size drop of blood is then taken up with a pipette and dropped into the mixture. If it sinks add more chloroform from a dropping bottle, if it tends to rise, more benzol. The mixture in which the drop of blood tends to remain stationary, near the top of the mixed benzol and chloroform, has the same specific gravity as that of the blood. This is determined by an accurately graduated hydrometer. The normal average specific gravity for men is 1059, for women 1056. A table, giving the Hb. percentage corresponding to the specific gravity, accompanies the outfit.
To determine the necessity for intravenous infusion in cholera Rogers has recently recommended the employment of small bottles containing aqueous solution of glycerine with specific gravities varying from 1048 to 1070, increasing the specific gravity in each successive bottle by 2°.
An accurate hydrometer will suffice to determine the specific gravity. Drops of blood from the cholera patient are deposited at the center of the surface of the fluid in the bottles from a capillary pipette. If the specific gravity of the blood is 1062 at least a liter of saline or sodium bicarbonate solution is needed. If 1066 at least two liters. Formerly he estimated the indications by blood pressure considering a pressure of 80 in Europeans or of 70 in natives as indicating intravenous injections.
Practical Application of Methods of Blood Examinations to the Various Tropical Diseases
In considering the value of blood examinations in the various tropical diseases we may first note those in which such examinations are of little or no value and second those in which such examinations are crucial or at any rate of prime importance.
1. In the First Group We May Include the Following:
Beriberi.—The leucocytes are about normal in number with possibly a slight increase in lymphocytes. Of course there may be anaemia present with the progress of the disease. Some think there is a slight diminution from the normal percentage of eosinophiles.
Noc found the percentage of lymphocytes in beriberi patients to be about 35 as against 32 for those unaffected.
Sprue.—There is considerable reduction in red cells which may fall below 2,000,000 in advanced cases. The whites may show a slight tendency to leucopenia with a relative increase in lymphocytes. The haemoglobin is not as much reduced as the red cells so that we obtain a color index of from 1.1 to 1.3.
Poikilocytosis and punctate basophilia are often noted, but rarely does one find nucleated reds. In a severe case the blood picture is rather that of an aplastic anaemia than a typical pernicious anaemia. The eosinophiles are rare or absent as the case advances. One often finds many (7-9) nodes in the polymorphonuclears.
Pellagra.—This disease may show a chloranaemia. Some authorities have stated that we have an increase in the percentage of large mononuclears but Hillman found a rather definite increase in the lymphocytes (34%) and a normal large mononuclear percentage.
Yaws.—This disease may show a moderate anaemia with a low color index. The leucocytes are about normal in number with a moderate increase in the percentage of large mononuclears.
Leprosy.—There is, as would be expected, with the progress of the disease, an anaemia which is of the chlorotic type. Leprosy bacilli may be found in the blood, especially during the time of the febrile accessions, but such examinations are of very little value in practical diagnosis and there are so many liabilities to error, as shown in the work with tubercle bacilli in blood, that we should be very conservative in this direction.
There is probably an increase in the percentage of lymphocytes.
Yellow Fever.—The blood findings are usually given as normal although Noc states that at first we have an increase in polymorphonuclear percentage to be followed by an increase in the large mononuclears about the fifth day. He also noted an absence or diminution of eosinophiles.
Intraperitoneal inoculation of animals with blood from patient should be practised. Should the diagnostic reliability of the procedure be established, yellow fever should then be placed in Group 2, among those diseases in which examinations of the blood are of prime importance.
Cholera.—As cyanosis develops the red count goes up even to 8,000,000 with a corresponding or greater increase in the leucocyte count. The estimation of the low blood pressure is important as indicating the necessity for intravenous injections. The determination of the degree of serum acidosis is also indicated with reference to alkaline treatment. In a convalescent from a disease suspected as cholera an agglutination test would be of value, and in the absence of the serum of immunized animals one could use that of a cholera convalescent against a spirillum isolated from the stool of a suspected case of cholera.
2. Of the Diseases in Which an Examination of the Blood Should Always Play a Part in Diagnosis May be Noted the Following:
Malaria.—The examination of the blood is necessary not only to prove the existence of a malarial infection but, as well, to determine the species of parasite present, this latter a matter of much importance as to prognosis and intensity of treatment according as one has to deal with a benign or malignant parasite. More exact information (and with the expenditure of much less time) can be obtained from a[540] smear stained with some Romanowsky modification than by examining a fresh preparation.
At the same time it is advisable to make a wet preparation and study it for amoeboid activity of the parasites and character of the pigment while awaiting the completion of the staining process.
In the blood of a malarial anaemia the central vacuolation of many of the red cells may give an appearance of young nonpigmented parasites. Malarial parasites tend to move about to take peripheral locations and furthermore they do not change in size upon focussing up and down as do the vacuoles.
Melaniferous leucocytes can be made out better in a fresh specimen than in a dried, stained one.
One can better differentiate species by an even thin film than by a thick-film method. There is often great doubt with a thick film as to whether the object noted is an artifact or a parasite. The Ruge thick-film method has given very good results.
There is only a moderate variation from a normal white count but in cases when the parasites are very scanty or when they have been driven from the peripheral circulation by quinine treatment we may make a tentative diagnosis of malaria on a leucocytosis during the paroxysm with a leucopenia during the afebrile interval with, at this time, an increase in the percentage of large mononuclears to 10 to 15%.
Melaniferous leucocytes are rarely noted in the benign tertian infections but in some of the very puzzling aestivo-autumnal fevers they may give the diagnostic clue.
Schüffner’s dots are yellowish dots in the infected red cells and are characteristic of benign tertian. The Maurer clefts of malignant tertian are less commonly noted. Always carefully note the pale, swollen, infected red cells of benign tertian, the shrunken degenerated cell of malignant tertian and the normal one of quartan. The fine hair-like ring of malignant tertian is often noted on the periphery of the red cell as a narrow line while the half-grown schizont of quartan is often seen as an equatorial band.
In the anaemia following malaria we may have very low red counts and haemoglobin percentages. They usually run parallel, so that the color index approximates 1.
Punctate basophilia is quite common in malarial anaemias. Up to the present time the culturing of the parasite can scarcely be considered an aid to diagnosis as it is difficult to carry the development beyond one generation so that we do not get multiplication of parasites. In cases where confusion exists as to the nature of the[541] species of parasite present culturing would help as regards the possibility of noting the developmental stages of Plasmodium falciparum.
Blackwater Fever.—The same points which hold for malaria hold for blackwater fever.
The striking feature of blackwater, from the side of the blood, is the rapid and great reduction in red cells and haemoglobin. As a result of the pathognomonic haemoglobinuria we may have in a few days a fall of red cells from 4 or 5 million to approximately 1 million with haemoglobin down to 20%. The color index is usually about 1. The blood is thin and the serum tinged. Probably from the excessive haemolysis one does not see degenerated cells as frequently as would be expected. Tests for acidosis and coagulability of the blood are indicated as there is a reduction in titrable alkalinity of the serum and coagulation rate.
Oroya Fever.—This disease, within two or three weeks, gives the blood picture of a marked pernicious anaemia. The rod-shaped protozoon may be seen lying in the red cells singly or in V-shapes.
These rods show a chromatin granule at one extremity. Normoblasts are very numerous and megaloblasts appear later. There is both polychromatophilia and poikilocytosis. The color index is that of pernicious anaemia, above 1. The leucocytes are increased to about 20,000 with 75% of neutrophiles, among which are many immature forms or metamyelocytes. The pathological process shows its greatest activity in the bone marrow.
Malta Fever.—In this disease blood cultures offer the surest and most practical way of making the diagnosis. The blood should be taken from a vein at the time of the height of the fever rise. To prevent coagulation the blood should be forced from the syringe into about an equal amount of citrated salt solution and subsequently added to melted agar to then be poured into Petri dishes. Cultures can also be made by smearing the citrated blood over poured plates of agar.
It must be remembered that the colonies are quite small and do not develop for four or five days.
The citrated blood can also be added to bouillon. The blood culturing has rather replaced the culturing from spleen juice. As the coccus is in the blood it is eliminated in the urine and plates should be made from the urine as well as the blood.
Malta fever is one of the diseases which can be diagnosed quite early by agglutination tests, the reaction often appearing before the end of the first week and often continuing for months after recovery. There is a liability to error when low dilutions are employed so that the former use of dilutions of 1 to 20 and 1 to 40 is no[542] longer advised. Probably a dilution of 1 to 100 would be sufficiently specific but dilutions of 1 to 500 and even higher are frequently obtained. It is now thought best to heat the patient’s serum to 56°C. for twenty minutes before applying the test so as to destroy nonspecific agglutinins. Opsonic index and complement fixation tests have been employed in diagnosis.
As the disease progresses a secondary anaemia develops. The white count is about normal but with the polymorphonuclears somewhat reduced in percentage and the mononuclears increased.
Some observers have reported a leucopenia as of some diagnostic value but others find the leucocyte count normal and Rogers considers the absence of leucopenia as differentiating kala-azar from Malta fever.
Plague.—In septicaemic plague blood cultures offer the surest method of diagnosis as clinically there may be very little to suggest plague. This is about the only disease in which one may find the causative bacterium in a blood smear. For this examination the thick-film method has been recommended. Just as with the material from a puncture of a bubo or the sputum from plague pneumonia we should employ animal inoculation as well as cultural procedures with the blood.
We usually have a marked leucocytosis due to a great increase in the polymorphonuclears. The white count may exceed 50,000. Just as septicaemic plague may so overwhelm the organism that it does not respond with fever so may the leucocytosis be absent. Bubonic and pneumonic plague tend to become septicaemic, so that in such types of the disease we may obtain results with blood cultures.
Liver Abscess.—Schilling-Torgau brings out the point that even with an absence of the usual blood findings it is possible to diagnose the disease and make a just prognosis with his method of differential counting. Ordinarily we have a leucocytosis of from twelve to twenty thousand with only about 70% of polymorphonuclears and about 12 to 15% of large mononuclears. When a bacterial infection accompanies the amoebic one of course the leucocytosis and polymorphonuclear percentage reach higher figures. The eosinophiles may entirely disappear in an uncomplicated case of amoebic abscess.
In comparing his method with the ordinary one Schilling-Torgau notes a case with a differential count showing 72% of polymorphonuclears, 17% of lymphocytes and 8% of large mononuclears with a white count of 6000—apparently a normal blood. By his method 33% of these neutrophiles were found to be of the band-form or less mature cells, thus showing that the blood really did deviate from the normal.
In other examinations he noted very unfavorable indications from the high percentage of metamyelocytes and even myelocytes when the ordinary count did not suggest the serious condition.
As stated previously this method would seem to offer many advantages over the ordinary one.
Trypanosomiasis.—While the blood, when examined in ordinary smears or with thick-film methods, does not give as good results as by examining the gland juice for trypanosomes, yet, by taking 5 or 10 cc. of blood in citrated salt solution with 2 or 3 centrifugalizations, we may obtain greater success in finding the parasites in this way than when using gland juice.
In wet preparations we may note the clumping of the red cells. This is the phenomenon of auto-agglutination thought by some to be rather characteristic of trypanosomiasis.
We may carry out the leucocyte attachment test using the inactivated serum of the suspected patient.
As the disease progresses we get a secondary anaemia. The leucocyte count is usually normal but the differential count shows an increase in the large mononuclears. Bacterial infections often supervene when a leucocytosis will be noted.
Kala-azar.—Quite recently there has been success in the diagnosis of kala-azar by culturing the blood of the suspect on N. N. N. medium. The key to success when culturing from the blood is to wait for two or three weeks before giving up the examination of the cultures. It will be remembered that almost invariably leishman bodies are present in the blood only in extremely small numbers so that there is not time by the end of a few days for sufficient development to have taken place. In probably 80% of cases the parasite of kala-azar may be found in stained smears from the peripheral blood but only after prolonged and patient search. They may be found phagocytized by large mononuclears or polymorphonuclears. Of course splenic puncture examinations show far greater abundance of parasites than blood smears but it is not without danger.
The marked anaemia of kala-azar does not appear until the earlier symptoms of fever and splenic enlargement have gone on for some time. Very characteristic and important in diagnosis, however, is the marked leucopenia of kala-azar, approximating 2000 leucocytes on the average. Again the white cells are only about in the proportion of 1 to 1000 red cells. There is an increase in the percentage of large mononuclears. Some authorities have reported an acidosis of the blood serum. Coagulation rate is delayed.
In kala-azar the coagulability of the serum is altered as shown by the formol-gel test. In this test, a drop of clear serum from the patient is placed on a slide which is then inverted over a watch glass containing a few drops of liquor formaldehyde. In cases of kala-azar the serum will solidify, appearing as an opaque, stiff jelly which adheres to the slide; while other sera will remain fluid, running off the slide when it is tilted. The reaction appears not to be specific since it has been reported for syphilis and other diseases.
Relapsing Fever.—The spirochaetes are not so numerous in the blood of the peripheral circulation in tropical relapsing fevers as in those of Europe.
The spirochaetes can best be seen in stained smears but the agitation of the red cells in a wet preparation by the motile spiral organisms is of assistance in their recognition. Dark-field illumination, India ink smears and Fontana’s silver method are used as well as Giemsa staining.
During the afebrile period the parasites disappear from the peripheral circulation.
If the disease is first seen during the afebrile stage we may try Lowenthal’s reaction, which consists in taking a drop of the blood of the suspected patient, mixing it on a vaseline ringed slide with the blood of a patient showing spirochaetes, then covering with a cover-glass and incubating for thirty minutes at 37°C. A positive reaction shows clumping and loss of motility of the spirochaetes.
Reports vary as to the white count but on the whole there would seem to be more evidence in favor of a moderate leucocytosis although some observers have noted a fall from the normal. The usual statements give a leucocytosis of from 12 to 15 thousand with a polymorphonuclear increase to between 75 and 80%. The statement is usually made that the normal percentage of large mononuclears helps in the differentiation of malaria. Kieseritzky has reported leucopenia and slight increase in lymphocytes.
The leucocyte count tends to be higher about the time of crisis.
Weil’s Disease.—This spirochaete infection is due to Leptospira icterohaemorrhagiae. The spirochaete has been found in the blood and has possibly been cultured anaerobically from the blood. The practical method is by inoculating guinea pigs with blood or urine sediment. Spirochaetes are found in the liver smears of the sick guinea pigs. In the first week of Weil’s disease we have a leucocytosis—later on a leucopenia.
Filariasis.—The sheathed embryos of Filaria bancrofti are found in the peripheral circulation at night only, hence F. nocturna, while those of F. loa are only to be found in the daytime, hence F. diurna. In the islands of the South Pacific the filarial infection is considered as[545] of F. bancrofti but the embryos are present in the peripheral circulation both by day and by night.
Instead of being uncommon it seems rather to be the rule to fail to find embryos in the blood preparations in cases showing marked evidences of filarial disease, as in elephantiasis, calabar swellings, etc. The positive blood findings are most frequent in those who do not as yet show symptoms. There has not yet been sufficient obstruction in the lymphatics to keep the embryos from reaching the blood stream.
In some countries where a large percentage of the population may show embryos in the peripheral circulation, manifestations of the disease are very rare.
We may examine the blood either with fresh preparations, when the movements of the embryos assist in their detection, or by staining dried smears. Haematoxylin staining is better than the Romanowsky one as the break in cells and other points are better brought out.
An eosinophilia is usually considered as constantly present but this is not invariable. The leucocyte count is about normal.
Dengue and Phlebotomus Fever.—In these diseases a leucopenia, which begins to show itself by the second day, is very characteristic.
The average leucocyte count is about 3500 and along with this we have a reduction in the percentage of polymorphonuclears to about 50%. Towards the end of the terminal fever we have an increase in the percentage of large mononuclears.
Bacillary Dysentery.—The agglutination tests are of little value in diagnosing the presence of or type of an infection with dysentery bacilli, as the agglutinating power does not appear until during convalescence.
It is now customary to use a polyvalent antidysenteric serum in treatment so that it is not very essential to ascertain the strain involved in an infection. As a practical matter we make our diagnosis of the presence as well as type of dysentery bacillus involved in an infection by isolating the organism from the dysenteric stool.
During the fever we may have a moderate polymorphonuclear leucocytosis.
Enteric Group of Fevers.—In fevers of atypical course in the tropics one must always remember that typhoid and the paratyphoid fevers are anything but uncommon and blood cultures should always be made when such suspicion arises. In some tropical regions paratyphoid A infections seem most common although the usual experience is to encounter the paratyphoid B infection more frequently. In temperate climates the noting of a moderate leucopenia with an absence of eosinophiles is important in the diagnosis of typhoid, but in the tropics there are so many intestinal parasites and skin infections productive of eosinophilia that we cannot attach any importance to such a finding.
Typhus Fever.—Plotz attaches importance to the culturing of B. typhi exanthematici from the blood of typhus cases, but the relationship is now regarded as not causal. Rickettsia bodies, which can be demonstrated in the louse or in capillaries at autopsy, are now considered to be the exciting organism.
A mononuclear leucocytosis has at times been reported.
Spotted Fever of the Rocky Mountains.—Injection of the blood of the patient into guinea pigs produces the disease in the animal. Frick has reported the finding of chromatin-staining bodies in the red cells of such pigs and Wolbach has found chromatin-staining bacteria in the endothelial cells of such animals. These bodies are now classed as Rickettsia.
These findings cannot as yet be considered of diagnostic value.
Various Helminthological Infections.—In the earlier stages of ancylostomiasis and schistosomiasis we have a rather notable increase in the percentage of eosinophiles but with the advanced stages of these infections, with severe anaemia, the eosinophiles may even be absent.
One should always keep in mind the very characteristic and marked eosinophilia of trichinosis when such a blood finding is encountered. There is often a leucocytosis of 15,000 to 20,000 in this disease.
In the urticarial fever stage of Japanese schistosomiasis the marked eosinophilia is of great assistance in diagnosis. One trouble about attaching importance to eosinophilia in the tropics is the confusion which is difficult to eliminate and which arises from infections with the more common but less important group of intestinal parasites such as Ascaris, Trichuris, etc.
The eosinophilia-producing characteristics of many skin diseases must also be kept in mind.
CHAPTER XLVI
THE CIRCULATORY, RESPIRATORY AND LYMPHATIC SYSTEMS
TOGETHER WITH ANAEMIA, HAEMORRHAGES
AND OEDEMA IN TROPICAL DISEASES
The Circulatory System
Beriberi.—Almost as important in diagnosis as the weakness of the legs, with anaesthetic and oedematous areas, is the early palpitation of the heart upon the slightest exertion. Later on as the vagal degeneration becomes more prominent we have a loss of the normal cardiac rhythm, to even become embryocardial, together with dilatation of the right heart, pulsating jugulars and various blowing murmurs, which are propagated into the vessels of the neck. The pulse is weak and rapid and this combination of a tumultuous heart action and weak pulse is striking. Blood pressure is below normal.
Cardiac involvement is also a feature of ship beriberi as well as infantile beriberi. In the latter a marked hypertrophy of the right heart is characteristic.
In yellow fever we have at first a high blood pressure. The pulse rate, which at first corresponds with the rise of temperature, soon shows Faget’s law—a falling pulse with a constant temperature or a constant pulse with a rising temperature. It is a markedly slow pulse after the third day. The blood pressure is low in the asthenic stage.
In dengue we do not have the rise in blood pressure but the slow pulse is quite a feature of many of the dengue-like fevers.
In blackwater fever the pulse is rapid and soon becomes weak and of low tension.
Plague shows a striking toxic action on the heart muscle so that we soon get a soft, dicrotic pulse, rapid from the first and soon becoming thready. Patients with plague may die from cardiac failure upon getting up from bed.
A rapid pulse, especially in the morning, is thought to be a feature of active leprosy.
In cholera the pulse is rapid and feeble during the stage of evacuation and with the onset of the algid stage we practically have a cessation of the circulation. The systolic pressure may fall as low as 65 or 70 mm.
Hookworm anaemia shows early and marked cardiac palpitation. The pulse rate averages about 110 and the blood pressure is low. There is often some right-side dilatation of the heart.
Malaria generally gives a small, rapid, high tension pulse in the cold stage to become full and bounding in the hot stage. A cardiac type of pernicious malarial fever has been described, particularly by the French.
Both Malta fever and bacillary dysentery tend to have a toxic effect on the heart.
Typhus fever is a disease which tends markedly to affect the heart. Along with faint heart sounds we have a rapid, low tension pulse. In bacillary dysentery the tendency to an increase in pulse rate is of some value in differentiating it from amoebic dysentery.
African trypanosomiasis shows a rapid pulse rate whether the case shows temperature or not. In Brazilian trypanosomiasis the parasites may tend to invade the cells of the heart muscle thus producing manifestations of myocardial disease. The parasite (Schizotrypanum cruzi) may also affect the adrenals, causing a low blood pressure along with other signs of Addison’s disease.
The Respiratory System
Sputum Examination.—We should make a routine of examining a fresh specimen of sputum as well as stained smears. It is in such a specimen we search for the ova of the lung fluke.
Frequently the material submitted for examination as sputum is simply buccal or pharyngeal secretion, or more probably secretion from the nasopharynx, which has been secured by hawking. It should always be insisted upon that the sputum be raised by a true pulmonary coughing act, and not expelled with the hacking cough so frequently associated with an elongated uvula. When there is an effort to deceive, some information may be obtained from the watery, stringy mucoid character of the buccopharyngeal material and also from the presence of mosaic-like groups of flat epithelial cells (often packed with bacteria).
The pulmonary secretion is either frothy mucus or mucopurulent material, and if the cells are alveolar they greatly resemble the plasma cells. At times these cells may contain blood-pigment granules (heart-disease cells).
In the microscopic examination a small, cheesy particle, the size of a pin head, should be selected. This should be flattened out in a thin layer between the slide and cover-glass and should be examined for elastic tissue, heart-disease cells, eggs of animal parasites, amoebae, and fungi. Echinococcus hooklets, Curschman spirals besprinkled with Charcot-Leyden crystals, and haematoidin and fatty acid crystals may also be observed.
Curschman spirals indicate bronchial as against cardiac or uraemic asthma. Charcot-Leyden crystals have no special significance, except in certain tropical diseases when these crystals often are present in paragonomiasis sputum and in the pus of amoebic liver abscesses discharging by way of the lungs.
It may facilitate the examination of the sputum for elastic tissue and actinomycosis and other fungi to add 10% sodium hydrate to the preparation.
To make smears for staining, the sputum should be poured on a flat surface, preferably a Petri dish, and a bit of mucopurulent material selected with forceps. A dark background facilitates picking out the particle. A toothpick is well adapted to smearing out such material on a slide. After using the toothpick it can be burned. When dry, the smear is best fixed by pouring a few drops of alcohol on the slide, allowing this to run over the surface, and then, after dashing off the excess of alcohol, to ignite that remaining on the film in the flame and allow to burn out.
In beriberi we have shortness of breath with the early cardiac palpitation. In acute pernicious beriberi the pulmonary congestion and oedema divide with the heart the terrible manifestations of such an attack. The diaphragm may become paralyzed in beriberi. Some authors refer to the dyspnoea of beriberi as the beriberic corset.
Paragonomiasis gives rise to a chronic cough attended with the expectoration of more or less bloody sputum containing ova. Haemoptysis is not infrequent. The physical signs on percussion are slight but may be more marked on auscultation.
Hirudiniasis.—In Northern Africa, as well as in many islands of the Orient, the drinking water of ponds may contain leeches and these water-leeches tend to attach themselves to the pharyngeal mucosa. They may also attach themselves to the tissues about the larynx. In these cases we not only have cough and haemoptysis but dyspnoea from laryngeal oedema. It is probable that cases of dyspnoea called halzoun, and due to the attachment in the region of the larynx of flukes (Fasciola hepatica), as the result of eating raw liver, may often be due to leeches, as the two affections occur in the same regions.
Plague pneumonia is characterized by profound prostration in a patient whose physical signs do not seem to justify such extreme illness. The rather abundant and watery sputum soon becomes sanguinolent. Herpes labialis is absent. Besides primary plague pneumonia which develops directly from contact with a former case we have a secondary pneumonia which develops in the course of a typical case of bubonic plague.
In malaria we have a slight bronchitis in the ordinary types and many recognize a pulmonary type of pernicious malaria.
Malta fever tends to show a bronchial involvement about the twelfth day of the disease. Crepitant râles, a moderate cough and slight dyspnoea may be noted. It was the presence of pulmonary signs along with the profuse sweating and anaemia of the disease that justified the designation Mediterranean phthisis.
In liver abscess the crepitation at the base of the right lung, following congestion incident to the abscess of the right lobe of the liver, is of value in diagnosis. Rupture of a liver abscess into the lung occurs in about 10% of cases.
In heat stroke we may have Cheyne-Stokes respiration and pulmonary oedema.
Japanese river fever often shows bronchial involvement and cough at the time of the height of the fever.
In ancylostomiasis cases with cough and bronchitis have been reported and it seems probable that such manifestations may be connected with the course of the larvae through the pulmonary passages to reach the intestinal tract.
The filarial embryos of F. bancrofti remain in the lung capillaries during the day and recently such embryos have been found in blood coughed up from the lungs.
Katayama disease may show a localized bronchitis early in the attack and from its rapid appearance and disappearance would seem to be a sort of patchy pulmonary oedema. This is connected with the passage of the larvae through the lungs.
Broncho-pneumonia is probably the most common complication of typhus fever.
An affection known as gangosa or rhino-pharyngitis mutilans causes great tissue loss about nasal and buccal cavity. The voice has a peculiar nasal quality. It is possibly a manifestation of tertiary yaws.
Kala-azar patients are often carried off by a terminal pneumonia probably connected with the leucopenia and marked diminution of polymorphonuclears.
In leprosy, also, the victims are frequently carried off by pulmonary tuberculosis.
Relapsing Fever.—In relapsing fever there is frequently a moderate bronchitis at the time of the first febrile accession.
Bronchial Spirochaetosis.—There is a condition which more or less resembles lobar pneumonia, even to rusty sputum, but without signs of consolidation, and with negative Roentgenograms, when we find spirochaetes in the sputum. Another type of bronchial spirochaetosis is when the clinical picture is more that of pulmonary tuberculosis. There is question whether these spirochaetes are causative or only accidental.
Cases have been reported where a phthisis-like condition was due to a mould infection (Monilia). While such a condition may be primary it is more often secondary in cachexias as may be the case with buccal Monilia infections (thrush) which occur in the victims of cachectic states.
Guha.—In Guam there is also a rather fatal capillary bronchitis affecting young children which goes under the name of epidemic asthma or, as termed by the natives, guha. This affection comes on during the rainy season and is attended with marked dyspnoea and slight elevation of temperature.
Nasal Myiasis.—In the tropical and subtropical parts of North and South America a fly, Chrysomyia macellaria, is apt to deposit its eggs about the nasal orifices of persons with an offensive discharge from the nose. The fly seems to be attracted by foul odors. The larvae which develop are called “screw-worms” on account of the segmental bands of bristles and tend to invade the various sinuses, causing great destruction of tissue.
The case sets in with signs of a very severe coryza, together with fever and marked frontal headache. The face becomes swollen, red, and tender in the region of the nose. As the larvae reach maturity they come out of the nose. A nasal douche of 15 parts chloroform in 100 parts milk is often efficacious in bringing away the larvae. At times Sacrophaga larvae may be found.
The Lymphatic System
Plague.—The buboes are the most characteristic feature of the more common form of plague, bubonic plague. There may also be slight enlargement and tenderness of the glands in septicaemic and pneumonic plague but many such cases fail to show any evidence of superficial glandular enlargement. In pestis minor the only feature suggestive of plague is the glandular enlargement.
Very characteristic of the glandular involvement in plague is the marked tenderness of such glands. The slight pressure of palpation causes some pain and a sharp punch over an affected gland, excruciating pain. So exquisitely painful are these buboes that the patient with groin or axillary buboes will flex the leg or extend the arm to relieve pressure. In about 70% of cases the bubo is located in the groin, with 15% to 20% for axillary involvement and 5% to 10% for the submaxillary or cervical region. There may be involvement of both deep and superficial glands of a region, such buboes giving a large area of induration. As a rule there is a single bubo. The bubo is formed not only by the glands but by a periglandular oedema which fuses the glands into a solid mass. The buboes tend to suppurate about the commencement of the second week, so that gland puncture with subsequent culturing for plague bacilli and animal inoculation should be carried out before this time as pyogenic organisms replace the plague bacilli upon suppuration taking place.
Trypanosomiasis.—One of the characteristics of the disease recognized as diagnostic more than 100 years ago is enlargement of the glands of the posterior cervical triangle (Winterbottom’s sign).
There may be general enlargement of the lymphatic glands which are rather hard, discrete and not bound down to the overlying skin. These glands may be somewhat tender or entirely painless. One of the most valuable methods of diagnosis of trypanosomiasis is by gland puncture, the juice obtained therefrom being examined in smear or inoculated into a monkey or guinea pig. Brazilian trypanosomiasis also shows glandular involvement.
Filariasis.—Varicose groin glands are frequently associated with lymph scrotum, chylocele or chyluria. The glandular masses are soft and doughy. The consistency is often that of a lipoma.
The overlying skin slips over the glandular mass. These glands are often mistaken for inguinal hernia. They do not give a tympanitic note and disappear slowly upon firm pressure with the patient lying down but return even with the pressure maintained upon assuming the upright position. There is no impulse on coughing. If a sterile hypodermic needle be inserted into the mass a chylous fluid slowly and persistently comes out of the needle drop by drop and this material may show filarial embryos.
The filarial worms Onchocerca volvulus obstruct the lymphatics and may give rise to swellings of considerable size along the course of the lymphatics.
Climatic Bubo.—The onset is gradual often accompanied by a low remittent type of fever. There is an absence of venereal sore.
These glands are only slightly tender and are often called fatigue glands as they produce a feeling of weariness after even moderate exercise. The inguinal glands of one or both sides are the ones involved but the overlying skin does not show the redness of a chancroidal or gonorrhoeal bubo. There is often a softening in the center of the affected glands.
Tsutsugamushi.—The glands which drain the area in which is located the ulcer at the site of the bite of the Kedani mite show swelling and tenderness.
Rat bite fever also shows glandular enlargement in the glands tributary to the healed infecting bite of the rat.
In tularaemia the lymph glands draining the site of the infecting bite become inflamed and swollen, often suppurating.
In leprosy the glands draining involved regions become enlarged but do not show a tendency to suppuration. The glands most frequently involved are the cervical and groin glands.
In kala-azar the recommendation has lately been made to excise the somewhat enlarged glands and make smears from a piece of such gland and then examine the smear for leishman bodies. Gland puncture has not given as satisfactory results.
It is often stated that the superficial cervical glands are enlarged in dengue but not in dengue-like fevers. I have not observed in the cases I have seen either constant or well marked glandular enlargements.
In yaws there may be glandular enlargement. According to Finucane the cervical glands are often involved in Fiji children. These glands do not tend to break down.
In pediculosis of the hairy scalp the scratching back of the neck may result in pus infection with enlargement of the tributary cervical glands.
American leishmaniasis.—Not only is there often enlargement of the lymphatic glands but likewise we may have lymphangitis lines leading from the ulcer to the glands. The glands may be large and painful and may remain enlarged after the recovery of the patient.
Anaemia
The old idea that tropical life produced an anaemia is no longer held, the view now being that such anaemic conditions are almost invariably due to some well recognized cause, the most important of which is malaria. Natives of the tropics may appear bleached out but show a normal red count and haemoglobin percentage. Chamberlain’s observations have shown that a residence in the tropics of approximately two years has no appreciable influence on the red cell count or haemoglobin content of the blood of white men and that the actinic rays do not seem to be operative in producing anaemia.
Malarial Cachexia.—Although the malignant tertian infection has the greatest tendency to produce anaemia yet any type may, when untreated, bring about the more or less profound anaemia with earthy skin, enlarged spleen, dyspnoea on slight exertion, and oedema of the ankles characteristic of malarial cachexia.
Oroya Fever.—In this disease we have what might well be termed a fulminating pernicious anaemia. The rod-shaped protozoon which attacks the red cells seems to be peculiarly active in the bone marrow, excruciating bone pains being quite a feature of the disease.
There may be a reduction in red cells to one million per c.mm. within a few days. Normoblasts are abundant and megaloblasts may be observed in the more severe cases. The anaemia is intense and 20% to 40% of cases die within two or three weeks. A severe anaemia in which the blood picture is that of pernicious anaemia may accompany infections with the Balantidium coli.
Blackwater fever may produce a fall in red cells almost as marked as in Oroya fever.
Sprue shows a slowly progressive anaemia which in the later stages of the disease may become extreme, going down to one million, with a fairly high color index.
Ancylostomiasis is along with malaria the disease to be first thought of in connection with anaemia. The splenic enlargement of malaria should be thought of, although the view has recently been advanced that the spleen may be enlarged in hookworm disease.
In advanced cases of hookworm disease, showing a picture of profound anaemia, there may be so few worms present that the method of making diagnosis by finding ova may be unsuccessful. I have seen a case of typical aplastic pernicious anaemia, confirmed by autopsy, undoubtedly following a vicious cycle set up by the hookworm infection, in which scarcely a worm was to be found in searching the intestines.
Kala-azar gives a marked anaemia with an earthy color of the skin. The leucopenia and splenic enlargement are characteristic and the finding of parasites confirmatory.
Malta fever is usually followed by a moderate anaemia.
The helminthic infections, besides hookworm disease, are always to be thought of in the presence of anaemia. Very important among these are rectal and vesical schistosomiasis as well as that from the Japanese schistosome, together with liver and lung fluke disease. Even the ordinary round-worm, Ascaris lumbricoides, is to be thought of in a tropical anaemia.
Cases of anaemia, in which no other demonstrable cause has been noted, have been thought to be due to trichocephaliasis.
Tropical dysenteries are often responsible for anaemia and in liver abscess the patient becomes quite earthy in color, provided no operation is performed. In chyluria there is a marked drain on the patient.
The anaemia in liver abscess is not so great as the muddy complexion would indicate. The emaciation is greater than the anaemia.
Haemorrhages
The loss of blood through haemoglobinuria and haematuria has been taken up under the urine. The haemoglobinuria is the pathognomonic symptom of blackwater fever. There is also recognized a haemorrhagic form of pernicious malaria with epistaxis and alimentary tract haemorrhages. Moderate haemoglobinuria may be found in severe cases of malignant tertian infections.
Yellow Fever.—During the asthenic period of the disease, which sets in about the fourth day, we have, as a result of the damage to the endothelial lining of the capillaries, various haemorrhages.
Of these the best known and most dreaded is that from the stomach, black vomit. The bleeding from the gums is apt to appear before that from the stomach. Not only may bleeding occur from the intestines but from any mucosa, as that of the nose, conjunctiva or vagina.
In vesical and rectal bilharziasis the perforation of the terminal branches of the portal vein by the terminal or lateral spined eggs gives rise to haemorrhages.
In dengue we may have an epistaxis at the time of the crisis of the first febrile paroxysm.
In dysentery the blood-admixed mucous stools are of diagnostic importance.
In endemic haemoptysis the operculated eggs of Paragonimus westermanni are to be sought for in the sputum.
In leprosy epistaxis may be an early sign.
The damage to the endothelial lining of capillaries in plague gives rise to frequent haemorrhages into the skin.
There is a question whether the hookworms abstract blood from the intestines, although tests for occult blood are deemed important by some authorities in the diagnosis of this disease.
The granulomatous lesions of verruga are markedly haemorrhagic.
Some consider ship beriberi to be of the nature of scurvy in which case one should have in mind spongy, bleeding gums and the intramuscular haemorrhages of scurvy.
Typhus Fever.—The petechial rash of this disease (mulberry rash) is a distinctive feature.
Oedema
Oedema, especially about the ankles, is to be looked for in all the secondary anaemias of the tropics, particularly malaria and ancylostomiasis.
Beriberi.—The oedema begins at first about the feet, especially about the dorsal junction of phalanges and metatarsus. It is characteristically pretibial. It may remain confined to the shin or go up to knees, scrotum, sternal region or trunk. It is generally symmetrical but may be unilateral. It may become a general anasarca, even in forty-eight hours.
The swelling of the face is at times enormous, the eyelids being so oedematous that the patient can see only by separating them with the fingers. The oedema is more solid than that of nephritis. It not only rapidly appears but disappears as rapidly.
The oedema of beriberi may involve the glottis (oedema of glottis).
Oedema of genital regions is less marked than in nephritis or cardiac disease. We may also have localized areas of oedema 3 or 4 inches in diameter.
Ship beriberi, which has points in common with both beriberi and scurvy, shows oedema which may be limited to the lower extremities[556] or generalized. Epidemic dropsy is a type of beriberi in which there are fever and an erythema over the dropsical areas.
Calabar Swellings.—These seem connected with infections with Filaria loa. The swellings originate suddenly and disappear in three or four days. They are hard and do not pit on pressure. These smooth swellings, often 2 to 4 inches in extent, are most often seen on arms, face or ankles.
In trypanosomiasis oedema of the face and especially of the eyelids may be striking. There may also be patches of oedema elsewhere.
In Katayama disease the urticarial areas of oedema have given it the name of urticarial fever.
A peculiar disease of North China, known as atriplicism, is caused by the eating by the very poor of a weed, Atriplex, common around Pekin. There is itching of the fingers, quickly followed by swelling. This tends to extend to the back of the hands and up the outer surface of the forearm. The face becomes so swollen that the eyelids may be closed.
CHAPTER XLVII
JAUNDICE AND THE LIVER AND SPLEEN IN TROPICAL
DISEASES
Jaundice
Although the appearance of jaundice immediately suggests a disease of the liver yet as a matter of fact those diseases of the tropics in which the liver involvement is the sole or chief feature rarely show marked jaundice.
In tropical hepatitis or congestion of the liver or, as it is often termed, tropical liver, there is rarely a distinct jaundice and if such occur it is only temporary. Such terms as earthy, muddy, sallow, sub-icteric or pale lemon tint are more often applied than jaundice.
Liver abscess rarely gives rise to a definite jaundice unless the abscess be so situated as to cause pressure on the bile ducts.
In clonorchiosis, or the liver fluke disease of man, jaundice is not a feature of the disease except in the very late stages.
In those liver cirrhoses associated with Katayama disease, malaria or kala-azar there is no typical jaundice.
The tropical diseases in which jaundice is an important diagnostic feature are yellow fever, blackwater fever, bilious remittent fever and relapsing fever.
Yellow Fever.—There are cases which succumb without having shown jaundice but immediately following death the yellowish discoloration has been noted. At autopsy the yellow fever cadaver is almost invariably deeply jaundiced.
Very important is the fact that the jaundice of yellow fever does not appear until late, about the third or fourth day. When jaundice appears earlier, as by the second day, the prognosis is almost surely a fatal one.
According to Dutroulau the designation red fever would be more appropriate for the deeply congested facies of a yellow fever case in its first days.
The icterus is more marked about the face, neck and upper parts of the trunk. The albuminuria precedes the jaundice.
Blackwater Fever.—In a typical case of this disease we have within a few hours a marked jaundice which tends to deepen. It is usually[558] more or less marked according as the haemoglobinuria may be. It does not show the tendency to persist as does the jaundice of yellow fever.
Bilious Remittent Fever.—The jaundice appears rather earlier than that of yellow fever but is rarely seen on the first day of the paroxysm as with blackwater fever.
Of great diagnostic value is the early appearance of bile-colored urine as different from the haemoglobin-tinged urine of blackwater. The albuminous urine of yellow fever is not apt to show any bile coloring in the first three or four days of the disease.
Relapsing Fever.—There is a clinical type of relapsing fever associated with jaundice and a high death rate which was first described by Griesinger from Egypt. This icteric type is not infrequent in Asia. This jaundice is late and the disease much resembles yellow fever. The enlarged painful spleen and the finding of spirochaetes in the peripheral circulation are essential to differentiation.
Weil’s disease.—Much interest has been recently aroused in Weil’s disease, or epidemic jaundice, on account of the frequency of the disease in soldiers in the Balkan campaign. While a spirochaete has been shown by Inada and others to be the cause, yet many workers have isolated paratyphoid B organisms from the blood of such cases. Frugoni obtained cultures of this organism from the duodenal fluid of 11 cases from 48 cases investigated. The accepted cause of true Weil’s disease is Leptospira icterohaemorrhagiae. The jaundice begins about the third day of an irregular fever. Like yellow fever these cases showed injection of the conjunctivae and albuminuria. There were, however, usually a leucocytosis and enlarged spleen.
In severe cases of spotted fever of the Rocky Mountains we may have a generalized jaundice. Rarely cases of typhus fever may show jaundice.
Alterations in Size of the Liver
There is only a slight enlargement in the ordinary case of tropical liver but in some cases it may extend 3 or 4 fingers’ breadth below the costal cartilages or rarely to the umbilicus.
In liver abscess the enlargement is a rather late feature, and the condition should be diagnosed before we have the assistance of protruding ribs and distention of the intercostal spaces. As the abscess is usually located in the upper portion of the right lobe the enlargement is usually upwards and is best made out with the X-ray, showing the cupola-like projection.
In kala-azar the liver does not begin to enlarge until after about three months from the time of onset at which time the spleen will be quite large. Decided enlargement is generally noted by the sixth month.
The liver cirrhoses due to schistosomiasis or malaria may show slight enlargement or no particular change.
Sprue is a disease which gives a decided atrophy of the liver. Some authorities have noted a decrease of the size of the liver in cholera. The liver of yellow fever is of normal size and is not associated with splenic enlargement.
In the tropics one must always keep in mind the possibility of a liver enlargement being due to syphilis.
Pains of the Liver
In tropical liver there is more a sensation of weight than one of pain. In liver abscess, however, there are painful dragging sensations and, at times, with abscess of the upper right lobe, pain referred to the right shoulder. There is a marked tendency to splint the liver as shown by the costal breathing and moderate rigidity of the right rectus. The patient tends to lie on his back as shifting to either side, especially the left, causes pain. The legs are drawn up to relieve tension. Any jolting of the liver in palpation is exquisitely painful.
When active suppuration is going on in the liver the pain may be of an acute throbbing character. With abscess of the left lobe the pains may suggest gastric disease while with an abscess of the concave surface of the liver there may be referred pain in the appendix region.
In blackwater fever and bilious remittent fever there may be tenderness of the liver as well as the more prominent pain in the spleen.
Epidemic jaundice shows tenderness of the liver.
In plague there is a marked congestion of the liver as of other viscera and there may be some tenderness.
The liver becomes tender as well as showing enlargement in infections with Clonorchis.
Splenic Enlargements and Pains
Splenic puncture has been carried out for diagnosis chiefly in kala-azar, malaria and Malta fever. Some authorities have reported fatalities from spleen puncture in kala-azar approximating 1% so that many advise the safer liver puncture to that of the spleen.
Spleen puncture would only exceptionally be called for in malaria as there is usually no difficulty in making the diagnosis from a blood smear. Malta fever can usually best be diagnosed by blood culture taken at the height of fever and recent work by Wenyon and others would indicate that blood cultures on N. N. N. medium might take the place of spleen puncture in kala-azar.
Kala-azar.—The splenic enlargement is the most conspicuous change in the disease, the spleen often reaching the umbilicus by the third month and later possibly filling up the entire left side of the abdomen. The coincident emaciation of the patient makes the splenic tumor more apparent. When first enlarging the spleen may be the source of considerable pain and tenderness.
Fluctuations in the size of the spleen have been noted in the course of the disease, diminution in size often attending severe diarrhoeal attacks. In spleen or liver puncture the needle must be dry so that the parasites shall not suffer distortion.
Malaria.—Splenic enlargement and tenderness are important points in diagnosis of malaria.
In acute malignant tertian infections the spleen is often diffluent so that it is liable to rupture upon slight injury. One should even exercise care not to palpate the spleen too violently and the possibility of accident should be thought of in making a spleen puncture.
The typical malaria spleen is the ague cake of malarial cachexia. Here we have a greatly enlarged spleen with a thickened capsule and firm consistence. This spleen may fill up one side of the abdomen.
Malta Fever.—The splenic enlargement in this disease usually corresponds about to that of typhoid fever. At times, however, the size may be so great as even to suggest kala-azar.
Relapsing Fever.—Splenic enlargement and tenderness are marked features in this disease, often being noted early in the course.
Blackwater Fever.—The spleen is painful and enlarged. The splenic enlargement in this disease and relapsing fever is important in differential diagnosis from yellow fever, a disease in which the spleen is unaffected.
The spleen may be enlarged in Japanese schistosomiasis as well as in rectal schistosomiasis.
Darling has recently noted that it may be difficult to differentiate the anaemia of malarial cachexia from that due to hookworm disease. As a matter of fact most authorities note a diminution in the size of the spleen in ancylostomiasis rather than an increase and splenic enlargement would certainly favor a diagnosis of malarial anaemia.
One point of distinction between spotted fever of the Rocky Mountains and typhus fever is that the spleen of the former disease is enlarged three or four times the normal, while that of typhus fever shows no increase in size. The palpable spleen of Rocky Mountain fever is firm instead of soft as with typhus fever.
CHAPTER XLVIII
THE CUTANEOUS SYSTEM AND THE ORGANS OF THE
SPECIAL SENSES
The Skin
Ringworm infections of the skin are so common in the tropics that one should always make an examination for the causative fungi when doubt as to the nature of the lesion exists. Another point is that many hyperaemias, incident to other diseases, seem to furnish a favorable soil for fungi; thus, not infrequently I have found abundant spores and mycelial structures in scrapings from the erythema of the early syphilitic secondaries. Again pruritic lesions may become infected with fungi as the result of scratching, which scratching may not only have this result but furthermore may obscure the dermatological characteristics of the primary disease.
The most expeditious way to examine for fungi is to treat the scales or hairs with a 10% solution of caustic potash or soda. Then crush between two slides; heat moderately over the flame and examine after from 10 to 30 minutes.
A very satisfactory method is to scrape the scales with a small scalpel, and smear out the material so obtained in a loopful of white of egg or blood serum on a glass slide. By scraping vigorously the serum may be obtained from the patient. After the smear has dried, treat it with alcohol and ether to get rid of the fat. It may then be stained with Wright’s stain or by Gram’s method. The ordinary Gram method may be used or the decolorizing may be done with aniline oil, observing the decolorization under the low power of the microscope.
Hanging-block cultures.—To make these, pour melted agar in a Petri dish and cut from the film so formed sections 1 cm. square. Place a section on a slide, inoculate and drop on a cover-slip. Another method is to allow a drop of melted agar, previously inoculated, to spread over a cover-slip which is then inverted on a concave slide.
Prickly heat is another condition extremely common in the tropics and the scratching to relieve the itching often leads to infection with fungi or pyogenic cocci.
Pellagra.—In no other general disease is the skin eruption of such importance in diagnosis and it is practically impossible to make a sure diagnosis of pellagra in the absence of an eruption or the history of an eruption.
The eruption tends to show itself in the spring but may first appear in the early fall. The lesions resemble a sunburn and burn instead of itch. The characteristics of the eruption are bilateral symmetry and sharp delimitation from the sound skin.
As a rule the lesions are dry and atrophic but more rarely, and usually in severe cases, the eruption may be moist and oedematous.
The backs of the hands are the most common sites for the eruption but frequently there is an extension up the forearm. The neck, the bridge and alae of the nose, the region back of the ears and the front of the chest are often involved. In children the feet and legs are frequently involved. Scrotal eruptions are early manifestations.
Leprosy.—In nodular leprosy we have the appearance of macules of greatly varying size and shape with a tendency sooner or later to symmetry. They tend to appear and recur in association with febrile accessions and, even when they have become permanent spots, they show increased redness, infiltration and tension when there is fever.
The color is rather that of a sunburn and may be uniform or the center may be pale with copper-colored periphery. These spots appear by preference on face, backs of hands, buttocks, extensor surfaces of extremities and back. They may mark the location of later developing nodules. At first they are oily rather than scaly. We soon note a disappearance of hair within the spot. These spots soon tend to become anaesthetic. The tubercles of leprosy are usually of a reddish-brown color.
In nerve leprosy the spots tend to appear on parts of the body usually covered by clothing, as scapular region, shoulders, arms, thighs or buttocks. The outline is ovoid rather than round and the spots may at first be hyperaesthetic rather than anaesthetic, as they later tend to become.
In circinate eruptions we often note a pale center with brownish-red borders. These borders may be hyperaesthetic while the centers show anesthesia. Bilateral symmetry is more common in this than in nodular leprosy.
Besides the spots nerve leprosy may show blister-like lesions on backs of hands and feet especially in the region of the knuckles. Ulceration may follow.
Malaria.—The most common cutaneous manifestation of malaria is herpes labialis. This is more common in benign types than in malignant ones. Urticaria is next in frequency. Malaria has seemed to be the cause of certain cases of purpura simplex.
In attributing skin manifestations to malaria one must always have in mind the scarlatiniform, urticarial and erythematous rashes due to quinine used in treatment.
Urticarial Fever.—In Japanese schistosomiasis the earliest symptoms are the urticarial rash and fever.
Plague.—Rarely cases of bubonic plague may show a small vesicle marking the site of the flea bite. Areas of necrosis of the skin, which are really sloughing patches, and incorrectly designated “carbuncles,” may be noted, especially over the site of the buboes.
In the later stages haemorrhages into the skin (petechiae) are common.
Trypanosomiasis.—Patchy areas of erythema are often noted in Europeans affected with this disease. These are frequently circinate with fading in the center and tend to appear on the trunk.
In natives a dry skin is more often noted.
Rat Bite Disease.—An eruption of purplish spots may accompany the fever. There is a resemblance to erythema multiforme.
Dengue.—The true eruption of dengue is the one that appears about the fourth or fifth day as a measles-like eruption, starting about wrists or ankles.
Kala-azar.—There is a darkening of the colored skin of the natives suffering from this disease and it is to this feature that the disease owes its name.
In Europeans the appearance is more that one sees in old malarial cachectics, an earthy gray color. The characteristics of cutaneous leishmaniasis are discussed under that heading.
Typhus Fever.—Gangrene is particularly a feature of spotted fever of the Rocky Mountains and typhus fever, chiefly of the scrotum and prepuce with the former and of the extremities in the latter.
The distinctions of the eruptions of these two diseases and of tsutsugamushi are given on page 445.
Tsutsugamushi.—A small necrotic ulcer with a dusky red areola, often located in the armpits or region of the genitals, marks the site of the bite of the infecting mite. From it a lymphangitis leads to the swollen glands. About the seventh day a macular eruption, which never becomes petechial, appears on face, then on trunk and extremities.
Tularaemia.—There is often a local lesion at the site of the bite of the infecting Chrysops. The tributary glands are swollen.
In ancylostomiasis the site of entrance of the infecting stage of the larvae is marked by a dermatitis—ground itch.
Tibial ulcers are also features of this disease.
In filariasis we not only have the bleb-like lesion of guinea worm infection but also the calabar swellings of Filaria loa. Elephantiasis and lymph scrotum are the best known skin manifestations of F. bancrofti, but there may also be present filarial abscesses. The tumors of O. volvulus are most often on sides of chest, are quite superficial with the skin freely movable over them.
Epidemic Dropsy.—It is a question, whether such a disease as epidemic dropsy is distinct from beriberi. An erythematous eruption about the face and a macular one of the trunk and extremities are usually stated to be features of this disease.
Juxta-articular Nodes.—This is a condition in which small tumors form under the skin especially in the region of the elbows. These bean to walnut-sized tumors of the subcutaneous tissues may also be noted about the knees. A fungus has been reported as cause but the present view is that the cause is unknown.
Oriental Sore.—This form of cutaneous leishmaniasis is especially common in Asiatic Turkey and Northern Africa. It begins as a small papule which eventually ulcerates, the sore scabbing over from time to time and again breaking down. Indolent granulations and a very protracted course are rather characteristic features.
American Leishmaniasis.—The most important point of differentiation of this form of leishmaniasis from oriental sore is the occurrence of ulcerating lesions of the mucous membranes of mouth or nose subsequent to the appearance of the oriental sore-like lesions on forearm, legs, trunk, or rarely the face. In Peru the term uta more properly belongs to the skin affections while espundia is the designation applied to the lesions of the mucous membranes. It may be stated that a form of oriental sore has been reported from Greece where mucous membrane ulcerations have been associated with the ordinary skin-type lesion.
Dermal Leishmanoid.—Brahmachari has described a form of generalized cutaneous leishmaniasis, bearing a superficial resemblance to leprosy, which may develop a variable number of months after apparent cure of kala-azar by antimony. Having found leishmania bodies in the lesions, he conjectured that some of the parasites survive the action of the drug, but with their virulence so attenuated that they can give rise only to a milder disease, a variant of cutaneous leishmaniasis, to which he gives the name “dermal leishmanoid.”
Note.—The special tropical diseases of the skin are discussed under their respective headings.
The Eye
Glaucoma.—According to Elliott glaucoma is very much more common in the East than in Europe. He states that simple chronic glaucoma is extraordinarily common in India. Often the only symptoms are retraction of the field, cupping of the disc and at a later stage impairment of the central visual acuity. He notes that the advancement of the disease is often as unobtrusive as it is relentless. These patients often only present themselves at the clinic in the late stages of the disease; thus at the Madras hospital the vision was only that of hand perception, or less, in 40% of cases.
Cataract.—The general impression is that cataract is more frequent in the tropical regions than in Europe and as bearing out this view Elliott notes that cataract among those Europeans who have served in India seems more frequent than among those who have remained in England. Cataract is also more common in the southern part of China than in the northern portion.
Lachrymal Obstruction.—Elliott notes the extreme frequency of this condition in India, and states that in the Madras Ophthalmic Hospital 125 operations for excision of one or both lachrymal sacs were performed in 1907.
Trachoma.—There are certain tropical countries where trachoma is a disease of the greatest importance. Thus in China its prevalence is great, as is also true of India, Egypt and Japan.
Outside of imported cases it is very prevalent in many parts of the United States.
In this disease there is hypertrophy of the conjunctiva, granule formation and subsequent cicatricial changes. Pannus and corneal ulcerations are frequent complications.
The disease is contagious through transfer of the secretion by hands or flies. It is usually considered as caused by the so-called trachoma bodies or cell inclusions, which are best brought out by Giemsa staining. The trachoma granules are yellowish, translucent bodies set in the reddened conjunctiva.
Leprosy.—The eye is more frequently involved in nodular than in nerve leprosy. In the former we have infiltration of the conjunctiva which may extend to the cornea.
The leprous nodules invading the palpebral conjunctiva tend to ulcerate and bring about various distortions of the eyelids, producing ectropion. Iritis, irido-cyclitis and irido-choroiditis are less frequent than conjunctivitis and keratitis. The optic nerve and the retina are only rarely involved.
In nerve leprosy the eye changes are chiefly connected with the lesions of the fifth and facial nerves. Ptosis and paralytic ectropion occur with frequency.
Ophthalmia and corneal ulcerations may lead to total destruction of the eye. The cornea may be anaesthetic. Paralysis of one or more ocular muscles may cause squint or diplopia.
Malaria.—It is questionable whether the forms of conjunctivitis and keratitis at times reported as due to malarial infection are not rather of other origin.
Iritis is rarely a complication of malaria.
Retinal haemorrhages may occur in malarial cachexia and cerebral types of pernicious malaria.
Another rare malarial complication is amblyopia. In this there is an optic neuritis with grayish-red disc and the loss of vision is not complete, while in quinine amblyopia the disc is white and the vision completely lost for a time.
Filariasis.—In that filarial infection caused by Loa loa, at one time designated Filaria oculi, there seems a special tendency for the adult worms to wander to the subcutaneous tissues in the neighborhood of the eyes or under the palpebral or ocular conjunctivae. When moving under the conjunctiva the worms cause marked irritation and at times pain.
There may be considerable swelling so that the patient cannot for a time see out of the invaded eye. It has been stated that the worms may enter the anterior chamber of the eye but this is questionable.
It is believed that lesions of the cornea and iris may result from the migrations through the body of the Onchocerca volvulus.
Trypanosomiasis.—Eye lesions are quite frequent in this disease these being keratitis, irido-cyclitis or conjunctivitis.
Oedema about the eyes is of importance in diagnosis. Eye lesions seem more common in Rhodesian trypanosomiasis. The atoxyl treatment of the disease may cause optic neuritis and blindness.
Tick Fever.—In the relapsing fever of South Africa iritis has been noted as occasionally occurring.
Yellow Fever.—In the period of onset a feature of the so-called “facies” of the disease is marked injection of the conjunctivae with sensitiveness to the light.
Rush likened it to the eye of a wild animal as contrasted with the less ferocious eye of bilious remittent fever which more resembled that of a domesticated animal. About the third day the earliest manifestation of jaundice presents itself in the ocular conjunctivae.
Ancylostomiasis.—Retinal haemorrhages may occur with marked hookworm anaemia. Stiles notes a fixed stare in hookworm cases, the eye itself somewhat resembling the eye of a fish.
Among other diseases showing ocular manifestations may be mentioned one associated with fibrous nodules in the upper lid due to a larval dibothriocephalid, Sparganum mansoni.
Bacillary Dysentery.—Quite a number of cases have recently been reported where along with an arthritic complication there has been conjunctivitis. In 6 cases of dysenteric conjunctivitis, Maxwell noted that 4 cases had arthritis and 3 of the latter showed anterior uveitis. The conjunctivitis lasted about a week. Relapses seem liable to occur. In none of the cases has there been recovered from the conjunctival secretion the organism of dysentery.
Cholera.—As a result of the loss of all body fluids the lachrymal secretion is scanty or absent and we have various conjunctival and corneal troubles unless the eye is frequently irrigated with normal saline. Vitreous opacities and cataract may follow cholera.
Beriberi.—In this disease there have been reported the following eye complications: (1) retrobulbar neuritis; (2) paralyses of the muscles of the eye and (3) decreased sensibility of the cornea and conjunctiva.
Night Blindness and Xerophthalmia.—Both of these conditions are quite common in certain parts of the tropics and the view that the heat of the tropics and the tropical sunlight were potent factors had precedence until our study of vitamine requirements showed the etiology to rest in deficiency of fat soluble A. It is now known that cod-liver oil is particularly rich in this vitamine and that in this agent we have our best preventive and curative agent for these eye conditions. It is well known that rats fed on a diet deficient in fat soluble A develop xerophthalmia.
Night blindness (nyctalopia) is best known among the crews of sailing ships, especially when becalmed in tropical waters, and some influence of sunlight was considered the cause, but we now know that it is among such personnel that ship beriberi and scurvy are prone to occur by reason of deficiencies in water soluble B and the antiscorbutic vitamines. In such a dietary fat soluble A would also probably be lacking.
In those parts of the tropics where famine conditions are common both night blindness and xerophthalmia are frequent in young children, not necessarily associated but frequently combined.
In a mild case of xerophthalmia there is a dry area of triangular shape extending from either side of the cornea and covered with a fine, whitish foam. In bad cases the whole eye may be dry, wrinkled and opaque and eventually the cornea may slough away and bring about destruction of the eye. There is very little pain attending this frightful condition.
Elliot notes that from earliest times it was the custom in China to treat these conditions with extracts of liver. We now know that liver and kidneys are glandular organs rich in fat soluble A although not so rich in this vitamine as cod-liver oil.
Typhus fever.—There may be a rapid development of cataract of the soft variety, particularly in young patients. Ocular palsies, especially of the third and sixth nerves may occur during the febrile period. Corneal ulcers are not uncommon during convalescence and may be severe and very painful, often accompanied by conjunctivitis and iritis.
The Ear
Aural Myiasis.—While the larva of Chrysomyia macellaria, known as the “screw worm,” is the one most frequently reported from the external auditory canal, yet many such cases have been connected with the larvae of Sarcophaga carnaria, Calliphora vomitoria and Anthomyia pluvialis. These larvae are usually deposited in the auditory canals of those with otorrhoea.
The symptoms are intense earache, giddiness and possibly convulsions. The larvae tend to perforate the tympanic membrane. Instillations of 10% chloroform in milk or the use of oils kill the larvae.
In the stuporous states of plague and typhus fever there often appears to be a state of deafness.
One must always keep in mind the ringing of the ears indicative of the physiological action of quinine. Permanent deafness may be produced by the long continued use of quinine.
In leprosy the lobes of the ears are special sites of preference for the nodules and I always palpate the lobes where the nodules are not distinctly visible.
The Nose
Nasal Myiasis.—In cases of ozaena certain flies appear to be attracted and to deposit their eggs at the nasal orifices. The larvae developing from the eggs of Chrysomyia macellaria, a fly common in[569] tropical America, are known as “screw-worms” and cause frightful destruction of the nasal structures.
They may bore into the adjacent sinuses. Marked frontal headache and a purulent or bloody discharge are symptoms. Great swelling of the nasal structures precedes the destruction of the cartilaginous and bony tissues.
Leprosy.—The nasal mucosa is apt to be the seat of leprous nodules. Those located on the septum may ulcerate and material from these ulcers show abundant leprosy bacilli. Alternations of dryness and hypersecretion of the Schneiderian membrane are among the early manifestations of the disease.
Epistaxis.—This is a feature of the early stages of leprosy often associated with rhinitis, in particular the alternation of coryza-like conditions with others characterized by dryness of the nasal mucosa.
There is also a peculiar nasal tone to the voice of lepers.
In yellow fever and plague epistaxis is often the first sign of the degeneration of the endothelial linings of the capillaries.
Gangosa.—A disease of certain islands of the Pacific, especially Guam, characterized by naso-pharyngeal lesions and a nasal voice, is known as gangosa.
In goundou we have exostoses from the nasal processes of the superior maxillary bones.
CHAPTER XLIX
THE URINE AND THE GENITO-URINARY APPARATUS IN
THE DIAGNOSIS OF TROPICAL DISEASE
The Urine
Of the chemical tests employed in the examination of urine that for the presence of sugar is rarely of value, as there is no tropical disease in which the presence or absence of sugar is of diagnostic importance.
The determination not only of the presence of albumin in the urine but, as well, of the variations quantitatively from day to day is, however, most necessary in many of the tropical diseases and particularly in yellow fever and blackwater fever.
Tests for Albumin.—The simplest and most reliable test for albumin is the heat test with the subsequent addition of a sufficient number of drops of 5% acetic acid to make the boiled urine acid and incidentally to dissolve any phosphates which may have separated out on boiling.
Ulrich’s test is a very simple one and only calls for reagents which are usually at hand. Heat a saturated solution of common salt, containing 2% of glacial acetic acid, and superimpose the urine to be tested upon the hot reagent. A ring shows the presence of albumin.
For Heller’s test, pour a small amount of nitric acid into a narrow test tube and, while holding the tube at an angle of about 45°, superimpose a layer of the urine to be tested, which is delivered drop by drop from a pipette and allowed to flow down the side of the tube.
This test can be converted into a quantitative one which is sufficiently accurate for clinical purposes. It is based on the fact that a specimen of urine containing 0.003% of albumin will give a perceptible ring at the layering of the urine and acid in two minutes. If the ring appears at once or in a few seconds the albumin content is greater. From the qualitative test an idea can be formed as to the amount of albumin which the urine contains, a heavy ring forming immediately showing a considerable albumin content. Probably the highest elimination of albumin is found in chronic parenchymatous nephritis where it may run from 1 to 3%. In an ordinary case of acute nephritis O.5% would be an average content.
Recently I have been using for both qualitative and quantitative albumin tests the following apparatus. This is simply a 5-inch piece of ¼-inch soft glass tubing heated at a point 2 inches from one end, drawn out for about 2 inches and bent to form a U-tube with one end shorter than the other. This form of tube enables one[571] to perform two tests with the same column of nitric acid and is easily cleaned and dried. They may be kept suspended around a glass tumbler’s rim. Taking up a small amount of nitric acid with a capillary bulb pipette it is deposited in the capillary curve of the bent tube. This acid pipette should be kept attached to the acid bottle. With a second pipette the urine is deposited in the short arm of the U-tube and the presence of albumin shows by a distinct ring at the junction of urine and acid in the clear capillary tubing. The long arm will serve for the introduction of a second specimen of urine for the albumin test.
For quantitative test we dilute the filtered urine with one or more parts of normal salt solution according to the intensity of the albumin ring. A very convenient way of making the dilution is with a graduated centrifuge tube. Make a one to ten dilution of the urine, mix and draw up with a bulb pipette and deposit in the short arm of the U-tube. A distinct ring forms in two or three seconds. Pour off one-half of the diluted urine and make up with an equal amount of saline. Deposit this one to twenty dilution in the long arm. The ring forms in about a minute. With further testing it is found that a one to forty dilution shows a perceptible ring in just two minutes. This final and successful dilution multiplied by 0.0033 gives the percentage of albumin in the urine (40 × 0.0033 = 0.13%).
Should it be desired to determine the nature of the proteids present either in urine or in exudates or transudates the following method is applicable. Determine the percentage of total proteid by the method employed above. Then throw down the globulins by the addition of an equal amount of a saturated solution of ammonium sulphate, filter and estimate the proteid content of the filtrate. The difference between that and the total gives the percentage of globulin. The filtrate is now treated with 5% acetic acid until a precipitate of nucleo-proteid ceases to form; the fluid is filtered and the clear filtrate (which should not show any turbidity with a drop of 5% acetic acid) is tested for its proteid content, which represents the serum albumin. When the combined percentage of globulins and serum albumin is subtracted from the total proteid percentage we have the percentage of nucleo-proteid.
Tests for Blood.—Very important in tests of the urine are those for blood. With an unaided eye a smoky colored urine, more or less reddish-brown in color, is suggestive in cases of haematuria, while in haemoglobinuria we usually have a more or less porter-colored, turbid fluid which, however, shows a clear haemoglobin-tinged fluid when centrifuged to throw down the haemoglobin casts and granular débris of the disintegrated red cells. Upon shaking such urine we get a pinkish foam instead of the yellowish one of icteric urine.
A strip of white filter-paper when partially dipped into urine shows pinkish-colored waves which are more deeply colored at the summit of the waves while the paper which absorbs bile-containing urine shows the yellowish color and waves less yellow at the summits of the colored waves.
For haematuria we may use either the microscopic method for the recognition of red cells or chemical ones. The red cell is best recognized[572] by the double contour of the 7.5 micron disk. Spores of moulds, which greatly resemble red cells, are smaller, usually not more than 5 microns.
The following technic is of the greatest value not only because it makes the red cells more distinct but because by staining the various epithelial elements it gives us more exact information as to distinction between the segmented nucleus of pus cells and the single one of renal cells. Make a streak of vaseline across a slide one inch from one end. Then deposit a drop of urinary sediment, taken up from the centrifuge tube with a pipette, about ¼ inch from the grease line. Then drop a large drop of Gram’s iodine solution on this sediment and then apply one side of a square cover-glass to the vaseline line and allow it to fall gently on the drop of sediment and stain. There is no current motion, and casts and other urinary elements remain under the cover-glass instead of floating out beyond the margins. It is well to examine the unstained sediment with a ⅔ inch objective before adding the iodine and applying the cover-glass, as one gets a better idea of casts with a low power and unstained than in any other way.
With haemoglobinuria we necessarily turn to chemical or spectroscopic tests which are also applicable to microscopically doubtful cases of haematuria.
For the detection of occult blood, the technique described on page 524 should be observed, and alkaline urines faintly acidified with acetic acid before examination.
Indicanuria.—In sprue and pellagra we have a rather marked increase in indican. It is probable that many cases of vague manifestations of neurasthenia with loss of physical and mental energy are connected with auto-intoxication rather than tropical heat or intestinal parasites.
Urobilinuria.—In conditions where there is a great destruction of red cells tests for urobilin are important. Plehn considers the presence of urobilin as of importance in the diagnosis of latent malaria, which is true, provided other causes for red blood cell destruction are excluded. Blackwater fever cases usually show an intense urobilinuria. Urobilinuria is also a sign of deficient functioning of the liver.
Bile Pigment Tests.—In conditions associated with the presence of bile pigments in the urine we may conveniently employ the Gmelin test in the following manner. Filter the urine several times through the filter and then touch the moist inner surface of the paper with a glass rod dipped in commercial nitric acid. A ring-like play of colors, green, blue, violet and red circle out from the spot touched. A green color must be noted for positive diagnosis.
Tests for bile acids seem to have but slight value in differential diagnosis.
A very simple and apparently quite reliable test for deficiencies in liver functioning is that known as Ehrlich’s aldehyde reaction. The reagent is a 2% solution of p. dimethylaminobenzaldehyde in equal parts of water and concentrated hydrochloric acid.
For the test treat 5 cc. urine with 5 to 10 drops of the reagent. Agitate a few minutes and a positive reaction is shown by a fine cherry-red color, thought to be due to urobilinogen.
The urine sample should be perfectly fresh and not long exposed to light.
Amount of Urine in 24 Hours
Normally a man passes about 1200 cc. of urine in twenty-four hours, a woman somewhat less. When the amount is under 750 cc. we have an oliguria. To consider a polyuria as present the patient should pass more than 3000 cc., as this amount may be considered the upper normal limit. In anuria we have a cessation of renal activity.
The disease in which anuria is most characteristic is cholera. During the stage of evacuation the urinary secretion becomes less and less along with the progressive failure of circulation and, during the algid stage, we have a suppression of urine.
The anuria seems to run parallel with an acidosis and intravenous injections of bicarbonate of soda solutions tend to prevent anuria. In the stage of reaction the favorable outcome is the reappearance of urine, which increases in amount to become a polyuria. In unfavorable cases the anuria continues.
In blackwater fever anuria may result from the blocking up of the renal tubules by haemoglobin casts.
Blackwater fever also shows an acidosis and alkaline treatment is here indicated. Blackwater urine is irritating so that there is vesical tenesmus with frequent urination.
The degree of renal involvement is of great prognostic value in yellow fever, and those cases where the oliguria goes on to suppression are apt to terminate fatally.
In heat stroke there is an oliguria or anuria which may be followed, during convalescence, by a polyuria. Marked irritation of the bladder, associated with suppression of sweating, may be indicative of oncoming heat stroke.
In dropsical beriberi there is an oliguria or, rarely, an anuria which with the rapid disappearance of the general body oedema may become an excessive polyuria.
Rarely one may observe a critical flow of urine in dengue at the time of the fall of the primary febrile accession.
Albuminuria
The disease in which this is of peculiar diagnostic and prognostic value is yellow fever. We expect albumin about the second day with a steady increase in amount during succeeding days of the fever. The degree of oliguria or rather anuria is of greater prognostic value than the degree of albuminuria. The albuminuria is of great diagnostic value in differentiating yellow fever from dengue.
Blackwater fever shows a great abundance of albumin with the appearance of the haemoglobinuria and diminishes as the color of the urine clears up.
In malaria albumin was present in 38% of benign tertian infections and 58% of malignant ones at Johns Hopkins Hospital.
The absence of albumin in beriberic urine is important in differential diagnosis from acute nephritis.
Haemoglobinuria
Paroxysmal haemoglobinuria or haemoglobinuria resulting from potassium chlorate poisoning, severe burns, intravenous injections of foreign sera, or—most commonly—syphilis, may be noted in the tropics.
The vast majority of cases of true tropical haemoglobinuria, however, are due either to blackwater fever or to the administration of the acid salts of quinine to one predisposed to quinine haemoglobinuria. While it must be admitted that haemoglobinuria may result from quinine it is certainly so rare in subtropical countries, where great amounts of quinine are administered in treatment of malaria, as to be unimportant. It is only where the malignant tertian parasite flourishes that we have the question of the importance of quinine in producing haemoglobinuria brought up.
Certain persons have isohaemolysins in their blood which dissolve the red cells of other persons and in paroxysmal haemoglobinuria autohaemolysins may be present which can destroy the patient’s own red cells. This auto-haemolysis seems operative only when a low temperature is followed by a high one. When haemoglobinaemia exists the liver converts it into bile pigment causing bilious stools and jaundice. If one-sixth of the red cells are destroyed haemoglobinuria results.
The dark, porter-colored urine of blackwater is diagnostic even to the patient. The urinary sediment consists of granular débris with occasional haematoidin crystals. Albuminuria runs parallel with the haemoglobinuria. Pain in the loins, probably, from the plugging of the renal tubules by the detritus of red cell destruction, is a feature of blackwater fever. In blackwater fever we have the early appearance, even in a few hours, in a patient who is markedly asthenic and miserable, of jaundice, porter-colored urine and albuminuria.
Haematuria
Among tropical diseases that which immediately suggests haematuria is vesical bilharziasis. The blood in the urine is in the form of red cells; it is a haematuria and not a haemoglobinuria. The passage of blood usually occurs at the end of micturition and it is either in the last few drops of urine or in the sediment obtained after centrifuging that we note the terminal spined eggs of S. haematobium which prove the diagnosis.
Red blood cells in the urine may also be noted in the haematochyluria of filarial disease.
When we have blood in the urine in yellow fever it is a haematuria and comes on about the same time as the black vomit and other haemorrhages resulting from degeneration of the endothelial linings of the blood capillaries, which only takes place about the third or fourth day of the disease.
Haematuria may also be noted in plague at the time when the haemorrhages into the skin occur.
Chyluria
Vesical varices from lymphatic obstruction, due to filarial disease, are the most frequent cause of the milky urine of chyluria. The urine usually has a pinkish tinge from blood admixture so that the condition is really a haematochyluria. The thoracic duct may not be the seat of obstruction which has taken place elsewhere when the condition is lymphuria instead of chyluria. Lymph and chyle differ in fat content, the former having from very little to about 3% while the latter has 5% or more of emulsified fat. Chyle has also more than twice as much proteid as does lymph.
In chyluria the morning urine is often clear while that at night is milky. On standing, chylous urine separates into an upper cream-like layer with a pinkish sediment and, between, a pinkish-white fluid in which floats a clot. Filarial embryos may or may not be found.
Kidney Function and Its Determination
The ability of the kidney to excrete substances from the blood stream is frequently affected by disease, especially such as disturbs the kidney, and is usually diminished after the age of 50 years. Disease of the kidney, however, does not necessarily imply an inability to eliminate substances—the functional need not parallel the anatomical lesion. Function may be normal especially when the changes are of focal type.
Impairment of renal function does not affect the excretion of different compounds to the same extent. It is well established that functions for chlorides and for urea are independent of each other. In any urinary examination, then, one should bear in mind the possible effect of an impaired excretory power relative only to the substance under consideration. In this connection, we speak of the kidney threshhold for a substance, i.e., the concentration required in the blood stream before the kidney will excrete it, at least in abnormal amounts. For chlorides, this is quite definite at 562 for blood plasma; for sugar, it is about 160-180 for whole blood. The threshold is not necessarily absolute, but simply indicates that with less sugar, for instance, only the normal traces will be passed. Chloride excretion begins only when their concentration passes the threshold value, and the rate of elimination depends upon their excess. Other compounds, such as urea, for example, may have no definite threshold value. Disease may affect the value, either by raising it and causing abnormal retention, or by lowering it and giving rise to depletion.
We can establish the status of the renal function in any given case, and are then in a position to intelligently prescribe dietetic and other treatment. Chemical analysis of the blood indicates the metabolic products affected and guides us in the adjustment of the diet, etc., to the excretory powers of the kidneys. One must, however, not overlook the nutritive needs of the body.
Many methods are employed for the determination of kidney function, and their relative values are still debatable. Probably those least open to criticism are chemical analysis of the blood, the phenolsulphonephthalein test, and Mosenthal’s method. Ambard, McLean, Van Slyke, and others have devised formulae to this end, based upon chloride, urea, or sugar excretion, which have many warm advocates as well as severe critics. A rough clinical comparison of the two kidneys may be obtained by determining the urea in specimens of urine simultaneously collected by the ureteral catheter.
Blood Chemistry, now that its value has been established, is generally given preference and allowed greater weight in case of disagreement with other tests. It measures excretory function for normal metabolic products, and has the additional value of an aid in diagnosis and prognosis and a guide to treatment, especially dietetic. It has the disadvantage of a possibly unfamiliar technique, and does not afford a comparison of the two kidneys.
The substances usually considered are the nitrogenous compounds (nonprotein nitrogen, urea nitrogen, uric acid, etc.), but retention of others (sugar, chlorides, cholesterin, etc.) are also of significance in this connection. Of the nitrogenous constituents, the kidney excretes creatinine most readily, urea next, and uric acid[577] with the most difficulty. As a consequence, an impairment of function results first in the retention of uric acid, then urea, and, finally, creatinine is also retained. Owing to the relatively small amounts of uric acid and creatinine present, the nonprotein nitrogen, which includes the nitrogen in them as well as in other compounds, is not appreciably affected except by the urea increase. This is the basis of an intelligent interpretation of the findings. The urea and nonprotein nitrogen are so markedly affected by diet, especially among nephritics, that judgment must be exercised when they are employed as indices of renal function. This fact was not properly appreciated until recently, and probably accounts for much of the discredit cast upon blood chemistry in this connection. The uric acid, being less exogenous in origin, is perhaps the most delicate and the safest index; the increase appears early, and 3.5 may be considered the high normal value. On the usual restricted hospital diet, over 20 for urea nitrogen should be considered suggestive of impaired kidney function; over 75 speaks decisively for renal involvement and probably uraemia.
Phenolsulphonephthalein (Phthalein, or Red) Test.—This was developed by Rowntree and Geraghty, and its simplicity makes it very useful, especially to the isolated practitioner with limited laboratory facilities. It estimates only function for a foreign substance, is not considered quite as reliable as chemical analysis of the blood, and, of course, does not give the additional information that the latter supplies. It is, however, of much value, has no contraindications, and does compare the kidneys when combined with ureteral catheterization or use of a separator. Positive results are of more significance than negative, and it is less affected by glomerular than tubular changes. Values of more than 75% for 2 hours may be accompanied by diuresis, and Frank considers such a finding suggestive of renal disturbance with irritation if there is any corroborative evidence.
The technique comprises administration of the dye, determination of the interval before it appears in the urine, and the amount then excreted during definite periods. The dye is employed in solution, and is conveniently purchased already sterilized in ampules, each containing slightly more than 1 cc. of a solution of its monosodium salt of the strength of 6 mg. per cc. The patient drinks 200-400 cc. water, and 6 mg. of the dye are injected intramuscularly (lumbar muscles), or intravenously, 20 minutes later. The bladder is immediately emptied, and the urine discarded. The succeeding portions of urine may be collected by voiding, but it is more accurate to catheterize the bladder or ureters, and catheterization is practically a necessity for determination of the “appearance time.”
The appearance time is the interval of time elapsing between injection of dye and its appearance in the urine. It is determined by allowing the urine to drip from the catheter into a receiver containing a drop of 10% NaOH. The first traces of the dye will cause a pink color.
The time interval chosen for calculating excretion is then computed from the instant of this appearance. There is considerable diversity in practice as regards this time interval, and it would seem that shorter intervals and quicker results are gaining in preference, as well as being considered equal in value to longer periods.
The percentage excretion of the dye is now measured in each sample of urine. To do this, prepare a standard solution, made by diluting 0.5 cc. of the phenolsulphonephthalein solution mentioned above to about 200 cc. with water, adding 5-10% NaOH until no further intensification of the red color is produced (requires a few cc.),[578] diluting to one liter, and mixing. This standard then represents 50% (3 mg.) of the amount of the dye injected. The color of the urine sample is similarly developed with alkali, and the mixture diluted to 1 liter, mixed, and compared with the standard in a colorimeter. The per cent excretion in the specimen equals the reading of the standard solution multiplied by 50 and divided by the reading of the urine mixture, when the colors are matched in the instrument.
For accurate work, it is desirable to balance in the standard the urine color of the unknown, and this is accomplished by including in the standard a volume of urine (dye-free) proportional to that in the unknown. Also, with a low excretion, it is better not to dilute the unknown to 1 liter, but to some lesser volume that will give a tint closer to that of the standard, and then allow for the variation in the calculation.

Fig. 153.—Fibres, starch granules, etc., which may be found in urine sediment. No. 12 gives appearance under microscope of scratches on old used glass slides. No. 15 (a), Tyroglyphus longior a mite. No. 15 (b), Trichomonas vaginalis. No. 16 (a), Egg of Eustrongylus; (b), Echinococcus hooklets; (c) Schistosoma egg; and (d), Filaria bancrofti embryo.
Dunning has devised a simple, inexpensive colorimetric outfit with permanent standards in ampules for this test. It is satisfactory unless the colors of the standards fade.
After intravenous injection, the normal appearance time is 4-6 minutes, and the normal elimination is 35-40% in 15 minutes, and totals of 50-65% for 30 minutes and 65-80% for 60 minutes; or, for the first 30 minutes, it may be stated as about 1% per minute from each kidney.
After intramuscular injection, the normal appearance time is nearer 10 minutes, and the normal elimination is 30-40% in 30 minutes, and totals of about 50% (40-60) for 60 minutes, and about 80% (60-85) for 2 hours, or 20-25% during the second hour. If the appearance time is not determined, it is customary to allow for it, collecting the first hour’s specimen at 70 minutes after injection of dye and the second hour’s 60 minutes later.
Impairment of kidney function, of course, increases appearance time and lessens excretion, serious cases not unusually excreting less than 1% during two hours.
When the question of the kidney involved arises, the urine must be taken by ureteral catheterization or by a separator.
Starches and Fibres.—In examining urinary sediments it is important to be familiar with the various textile fibres and starch grains which are so frequently present, the fibres coming from the clothing and the starch grains from dusting powders. Wool fibre fragments show bark or scale-like imbrications and are round. Cotton fibres are flattened and twisted, while linen ones show a striated flattened fibre with frayed segments as of a cane stalk. Silk shows a glass-like tube with mashed-in ends.
Corn and rice grains are the most common of the starch grains and their nature is immediately disclosed by their blue color when mounted in iodine.
Affections of the Genito-urinary Organs
In blackwater fever we have marked pain in the region of the kidneys due to the plugging of the tubules with haemoglobin casts. Vesical tenesmus and pain along the ureters may also be present.
In malaria Thayer states that nephritis occurs in about 2% of malignant tertian cases.
In bilharziasis the kidneys are involved secondarily—the change being brought about by stone in the bladder and cystitis leading to hydronephrosis and pyelonephritis.
Cases of cystitis occurring in dysentery have been reported which showed amoebae in the sediment of the urine. Such cases probably were connected with recto-vesical fistulae caused by amoebic ulceration.
In cholera the kidneys are markedly affected, especially the epithelial lining of the tubules.
Malta fever may rarely be attended by an orchitis.
One of the manifestations of filarial disease is lymph scrotum in which the scrotum is covered with small blebs containing a chylous fluid which may possibly contain microfilariae. It is associated with recurring attacks of lymphangitis. There is also a filarial orchitis and we may have a lymphangitis of the lymphatics of the cord. Again filarial disease may show a chylocele in which the tunica vaginalis contains a fluid similar to that seen in the varices of lymph scrotum. This fluid may also show filarial embryos.
In endemic funiculitis there is a sudden onset with high temperature and pain in spermatic cord and epididymis. The general condition rapidly becomes grave with a hard, tender, cylindrical swelling along the cord and also pain and swelling of epididymis. It is a streptococcus infection usually engrafted on a filarial or bilharzial process and demands immediate surgical measures.
Kala-azar may be accompanied by sloughing of the scrotum at the time manifestations of cancrum oris are noted.
Cases of gangrene of the scrotum have been reported as connected with malaria.
Gangrene of the scrotum and penis is not infrequently noted in Rocky Mountain fever.
In puzzling febrile cases in the tropics one should always think of a possible pyelitis. Then too keep in mind renal tuberculosis.
If leprosy comes on before puberty the sexual organs remain in an undeveloped condition. Leprous infiltrations are noted in the testicles and ovaries. In nerve leprosy, which does not usually come on until after puberty, the women may bear healthy children and it is now thought that the view that leprosy markedly tends to produce sterility is lacking in confirmation.
In ancylostomiasis menstruation is markedly interfered with and amenorrhoea is often a prominent symptom. Young men who have been affected before puberty show lack of development of pubic hair along with infantile genital organs. The girls do not show normal breast development.
Granuloma of the pudenda is a disease which is rather frequent in British Guiana.
Dhobie itch is characteristically located in the crotch region.
Bacteriological Examination of Urine
About the only tropical disease in which a bacteriological examination of the urine is of particular value is that in connection with Malta fever. It is advisable to cleanse the meatus with alcohol and then having discarded the first ounce or so of the urine to receive the remainder in a sterile salt mouth bottle. A drop of this urine can be deposited on a poured agar plate and smeared out over the surface.
As dysentery bacilli and cholera spirilla are practically absent from the blood, urine examination for the causative organisms in these diseases is fruitless.
The culturing of the urine to find paratyphoid or typhoid organisms should be carried out, as well as blood cultures, where we are dealing with puzzling fevers in the tropics. The Teague plating medium described under the chapter on Faeces is a very satisfactory one.
In culturing urine from a case of pyelitis blood agar is a most excellent differentiating medium for streptococci.
CHAPTER L
THE FAECES AND THE ALIMENTARY TRACT IN TROPICAL
DISEASES
The Faeces
It is advisable to examine a stool macroscopically before taking up the microscopical examination. Pus or blood in stools may often be noted without the aid of the microscope.
The normal stool is sausage-shaped and soft.
The mucus of bacillary dysentery is opaque and grayish from the great number of pus and phagocytic cells. It is well to remember that Charcot-Leyden crystals, which are practically always absent from bacillary dysentery stools, are not infrequent findings in the amoebae-containing stools; of course, these crystals appear in other intestinal parasite infections.
In obstruction of the common bile duct we have acholic, whitish, foul-smelling stools. If the putty color be due to bacterial change exposure to the air will restore the brownish tinge.
Sprue stools are whitewash to putty-colored, pultaceous, and filled with air bubbles. The amount is excessive.
A very practical way of obtaining amoebae is to pass a rectal tube or a piece of drainage tube with fenestrations into the bowel, and amoebae may be found in the mucus filling the perforations in the tube.
Ordinarily the stool is best collected in quart fruit jars and examined as soon after evacuation as possible. The wooden spatula-like tongue depressors are well adapted for handling the specimen.
In examining a stool, it is well to color the drop of faeces, which is to be covered with the cover-glass, with a small loopful of ½% solution of neutral red. If diluting fluid is used, it should be salt solution, and not water. The neutral red tinges the granules of the endoplasm of amoebae and flagellates a very striking brown-red color, thus differentiating them from vegetable cells or body cells.
Encysted protozoa are difficult to diagnose, unless one possesses considerable experience. In examining for encysted amoebae as well as for bringing out the number of flagella of flagellates I now use the following method: Take a clean slide and make a vaseline line across it about 1 inch from the end. A drop of the iodine solution is placed on the slide about ½ inch from the vaselined line and a suitable portion of the faeces to be examined is emulsified in it. The edge of a square cover-glass is then applied to the vaselined line and allowed to drop on the preparation. By pressure suitable thicknesses of fluid can be examined. There is an absence of current motion.
Epithelial cells are generally more or less disintegrated. In the mucus of bacillary dysenteric stools, however, large intact phagocytic cells are frequent, which may be mistaken for encysted amoebae, and the polynuclear cell count averages 90% as contrasted with the average polynuclear count of 7.5% in amoebic dysentery.
When a smear preparation is desired, we may smear out a fragment of mucus and stain by Romanowsky’s or Gram’s method. Beautiful preparations may be made by mixing the faeces with water, then centrifuging for one minute. This throws down vegetable débris and crystals. Now decant the supernatant fluid, which holds the bacteria in suspension, and add an equal amount of alcohol. Again centrifuge, decant, and smear out and examine the bacterial sediment.
Simply taking a small mass of faeces and emulsifying it with a wooden toothpick on a concave slide in 70% alcohol—then, after the sediment settles, taking up a loopful with platinum loop from the surface and smearing out, gives a very satisfactory smear. Gram’s method, with dilute carbol fuchsin counterstaining, gives the best picture.
To culture for typhoid, dysentery, cholera, or other bacteria, take up the material in a tube of sterile bouillon and smear it out with a swab over a lactose litmus agar plate or an Endo or Conradi-Drigalski plate. Before streaking the plates they should be very dry on the surface. This can be best done by pouring the melted agar into a plate with a circular piece of filter-paper in the lid and placing in the incubator for one-half hour to dry. The filter-paper absorbs the moisture. Then inoculate the surface of the plate with the faecal material.
Teague Medium.—We have formerly preferred the Endo plate for typhoid work and the lactose litmus agar when culturing for dysentery bacilli. More recently we have obtained most satisfactory results with the Teague medium. The colon colonies, after eighteen hours, are deep black and opaque while the typhoid-dysentery group show colorless, transparent colonies.
The medium is prepared as follows: Nutrient agar is made in the usual way, containing 1.5% agar, 1% Witte’s peptone, 0.5% sodium chloride, and 0.5% Liebig’s meat extract, to the liter of distilled water. It is cleared with egg-white, placed in flasks, and sterilized in the Arnold sterilizer on three successive days. The reaction is brought to plus 0.8. The agar is melted and saccharose 0.5% and lactose 0.5% are added. The medium is then heated for ten minutes in the Arnold. To every 50 cc. of the medium are added 1 cc. of 2% yellowish eosin and 1 cc. of 0.5% methylene blue. The mixture is shaken and plates poured. Eosin solution should be added first.
Occult Blood.—In performing the test for occult blood, one should exclude the possibility of blood reaching the bowels from an extraneous source, such as ingested foods, mouth, nose, lungs and vagina, and the absence of interfering substances should be ensured. An absolute milk diet, or, at least, a diet containing neither meat nor green vegetables,[583] is indicated for two or three days prior to the test, and all medication should be suspended. The technique noted on page 524 should be followed scrupulously when dealing with faeces.
It has been suggested that the absence of occult blood from the faeces may be accepted as an indication of cure in ancylostomiasis.

Ova in Faeces.—It is in the faeces we examine either for the parasites or for their ova in connection with practically all the flukes, except the lung fluke and the bladder fluke; for intestinal taeniases and for practically all the round-worms, except the filarial ones.
In the tropics, the examination of the faeces exceeds in value that of urine and is possibly more important than blood examinations.
Helminthiasis Statistics.—There is one point in connection with the statistical reports as to the presence of intestinal parasites in a given section of the tropics that I desire to emphasize.
Because a limited district shows a certain prevalence of intestinal[584] parasites we should not conclude that the entire country from which such findings emanate shows a similar extent and type of infection. Take for instance the Philippine Islands.

In 1910, there were made in Cavite Province 932 stool examinations upon specimens from cases of sick people and of these only such patients as it was thought required such an examination for diagnostic reasons were made to bring such a specimen of faeces.
Of the 932 examinations, 135 or 14.4% failed to show the presence of intestinal parasites or their ova. The remaining positive examinations gave findings as follows:
| Organism | Number of infections | Per cent. |
| Ascaris | 627 | 67.2 |
| Trichocephalus | 607 | 65.1 |
| Flagellates | 135 | 14.4 |
| Amoebae | 111 | 10.9 |
| Hookworm | 23 | 2.4 |
| Taenia saginata | 3 | 0.3 |
| Balantidium | 1 | 0.1 |
| Strongyloides | 1 | 0.1 |
At Bilibid Prison, Garrison encountered amoebic infection in 23% of the cases. In the medical survey of Taytay, his findings were 2.7%. Rissler and Gomez report only 0.39% of amoebic infection in their examinations in Las Piñas and no cases showing such infections in Tuguegarao and Santa Isabel. Such numbers are in striking contrast with those of former investigators, some of whom have reported as high a percentage of infection as 70.

Our findings as regards flagellates (14.4%) corresponded fairly closely with those of Garrison, namely, 21% at Bilibid and 5.5% at Taytay.
Garrison, for Trichocephalus infection, obtained 59% at Bilibid and 77% at Taytay; Rissler and Gomez give 53% at Las Piñas; 25.9% at Tuguegarao, and 6.23 at Santa Isabel. Our findings were 65.1%.
As regards Ascaris we found a higher rate of infection than for any other parasite (67.2%). Garrison encountered 26% at Bilibid and 82.9% at Taytay. The percentages of Rissler and Gomez are 77, 73, and 60 respectively for Las Piñas, Tuguegaroa, and Santa Isabel.
Garrison noted at Bilibid an incidence second only to Trichocephalus for hookworm infection, namely 52%. His percentage of infection at Taytay was 11.6. Rissler and Gomez found 11.14% of all cases examined infected with hookworms at[586] Las Piñas, 8.01% in Tuguegarao, and 45.38% in Santa Isabel. We noted only 2.4% for Cavite, San Roque, and Caridad.
Our findings as regards Strongyloides (0.1%) were far below those reported by Garrison at Bilibid (3%) and at Taytay (0.7%). Rissler and Gomez found 2.24% infected in Las Piñas, but no cases were encountered in Tuguegarao and Santa Isabel. The same factors influencing hookworm infection in this locality may be operative for Strongyloides. Garrison found 0.2% of the individuals examined at Taytay to be infected with ciliates, while Gomez and Rissler failed to find such infections at Tuguegarao or Santa Isabel. We found a single case in the 932 examinations.

Fig. 157.—Microscopical constituents of faeces. (v. Jaksch.) a, Muscle fibres; b, connective tissue; c, epithelium; d, leucocytes; e, spiral cells; f, g, h, i, various vegetable cells; k, “triple phosphate” crystals; l, woody vegetable cells; the whole interspersed with innumerable microorganisms of various kinds.
The Alimentary Tract
The Mouth
In pellagra we have moist fissuring at the angles of the mouth with a large indented tongue with central coating and bare tip and sides. There is often a glairy mucus covering these red borders on the side. The fungiform papillae are prominent. Later on the tongue may become fissured and uniformly red. The buccal mucosa shows a carmine flush. The gums are tender but there is not the tendency to aphthous ulcers one sees in sprue. The flow of saliva is frequently increased.
In sprue there is at first great sensitiveness of the buccal mucosa so that articles of moderate pungency give rise to painful burning sensations. The tongue becomes quite sore with vesicle formation along borders and tip which soon turn into ulcers. Ulcerations also occur on the buccal mucosa, particularly at the site of the posterior upper and lower molar teeth (Crombie’s ulcer).
The congestion causes a great increase in mucus especially about the faucial pillars and pharynx. Ulcers are common about the fraenum of the tongue. While the tongue is coated at first with red ulcerated tip and sides it later becomes bare of any coating, red and finally even glazed as though varnished. It is at times fissured.
Onyalai.—A very peculiar disease of Portuguese West Africa and possibly the Soudan region, known as onyalai is characterized by the appearance of blood-distended vesicles of the mucosa of the cheeks and hard palate. The tongue is often swollen. The skin may show haemorrhages and haematuria is not infrequent. The mouth blebs vary in size from that of a split pea to a diameter of ½ inch or more. The cause is unknown.
Herpes labialis is not so common in tropical as in temperate climate malarias. It is absent in plague pneumonia.
In leprosy the nodules which form on the inside of the cheeks and fauces tend to show ulceration and thickenings. The discharges from the ulcerations in the nose, especially that on the vomer, reach the pharynx and such leprosy bacilli-containing discharges may be expectorated and cause one to consider the material as coming from the lungs.
In yellow fever the bleeding from the gums usually precedes the black vomit.
In kala-azar and possibly in malaria we may have gangrenous conditions of the cheek, as cancrum oris.
In the miliary type of verruga we may have the granulomatous lesions appearing on the mucous membranes of the mouth.
In typhus fever the mouth is strikingly foul with marked sordes covering the teeth. The dry brown tongue in this disease is known as the “parrot tongue.”
We may rarely have parotid gland enlargement in Malta fever, malaria and tsutsugamushi.
Parotitis is not uncommon in typhus fever. A type of parotitis which differs from mumps in not being contagious has been reported from the Philippines.
Stomach and Oesophagus
Very important in diagnosis is a tenderness in the pyloric end of the stomach, which is brought out by attempting to palpate the epigastric region. It is marked in yellow fever and acute pernicious beriberi as well as in blackwater fever and bilious remittent fever. We also frequently have epigastric tenderness, extending to the right, in ancylostomiasis.
Hookworms patients are often “pot-bellied” and the craving for eating unusual articles, as earth, may be connected with the gastric hyperacidity which the patient desired to neutralize with alkaline earth.
Sprue gives a flatulent dyspepsia with gaseous eructations.
Pellagra gives eructations and pyrosis and very common is a burning sensation going up from the stomach along the line of the oesophagus.
The esophagus is raw in sprue so that swallowing is painful.
Nausea and Vomiting
So many diseases are attended with nausea, besides those in which nausea is accompanied by rather constant vomiting, that it would hardly seem advisable to consider it alone. At the same time the slight nausea which often accompanies bacillary dysentery, as one of the manifestations of toxaemia, is of value in differentiating this type of dysentery from the amoebic one.
In yellow fever there may be early vomiting of whitish or bile-stained mucus but the well-known black vomit is a later feature, only occurring after the fourth day when the other haemorrhagic manifestations set in.
Bilious vomiting is the feature in bilious remittent fever which causes the patient the greatest distress.
In blackwater fever the frequent retching and bilious vomiting tend to exhaust the patient and the persistent vomiting of green bile often precedes death.
Bilious vomiting may be quite a feature of the icteric type of relapsing fever.
Vomiting sickness.—There is a disease known as vomiting sickness which has been noted in Jamaica. It occurs chiefly in children and has a sudden onset with marked vomiting followed by cerebral symptoms and great mortality. Some have thought the disease to be yellow fever but the fever and jaundice of that disease are absent. Scott has thought it to be epidemic cerebro-spinal meningitis, but more recently has suggested that it is possibly due to the eating of some poisonous substance, plant or otherwise, and that it is not an infectious disease. It is now recognized as due to ackee poisoning.
Vomiting is often a sign of dangerous vagal involvement in acute pernicious beriberi. Some consider that the extreme dilatation of the right heart, pressing on the stomach, may be the excitant of this vomiting.
The vomiting of cholera follows the diarrhoea. The material vomited may be of the same character as the rice-water stools.
In ptomaine poisoning vomiting precedes the diarrhoea.
Rarely a liver abscess may burst into the stomach, in which case we would have the vomiting of pus. Of course the more common route is by the lungs in which case the chocolate-colored liver abscess pus would be coughed up instead of vomited up.
The Intestinal Tract
It is usual to consider constipation as a clinical feature of such diseases as plague, yellow fever, Malta fever, beriberi and tsutsugamushi, as well as typhus fever.
Abdominal pains are most often connected with dysenteric conditions and it is customary to state that the greater the tormina, or intestinal griping, the nearer is the dysenteric process to the caecum.
In cholera the cramping of the abdominal muscles may follow that of the calf muscles.
In sprue we may have a doughy sensation on palpating the abdomen due to the fermenting contents of the intestine.
In the algid type of pernicious malaria the abdominal griping may be severe.
Tenesmus is the condition which along with tormina gives a diagnosis of some form of dysentery.
In rectal schistosomiasis the thickenings and blood extravasations, resulting from the eggs extruded by the fluke, may give rise to prolapse of the rectum. This may also occur in severe bacillary dysentery and in a disease of British Guiana and Venezuela, known as epidemic gangrenous rectitis, prolapse and gangrene of the rectum may occur. The symptoms are those of gangrenous dysentery.
Diarrhoea
The chronic diarrhoeas of the tropics are often associated with amoebic dysentery and in such cases we generally get a history of recurring attacks of diarrhoea separated by periods of constipation.
In sprue the condition generally sets in as a morning diarrhoea, very profuse and painless. Hill diarrhoea also shows frequent stools of whitish color from early morning until about noon.
The typical stool of sprue is a gas-permeated, putty-colored, offensive mass, extraordinarily copious.
In cholera the rice-water stool, which is not attended by pain, causes an unusual sense of prostration even at the onset of the stage of evacuation.
In pellagra we often have a recurring diarrhoea or mild manifestations of dysentery.
The stool of pellagra is darker and less copious than that of sprue and shows only a normal fat content while that of sprue is very fatty—as much as 30% of ingested fat appearing in the sprue stool as against the 5% for the normal one.
In Japanese schistosomiasis, following the stage of urticarial fever, we have our best diagnostic means in examining the blood-tinged bit of mucus capping the stool for the spineless ova of the fluke.
The fluke diseases of the liver and intestines give rise to various disturbances. The diagnosis is by the finding of the specific ova.
In infections with Strongyloides stercoralis there may be vague manifestations of neurasthenia and diarrhoeal disturbances. Cochin China diarrhoea was once thought to be a Strongyloides infection.
Infections with amoebae, intestinal flagellates and ciliates are discussed under dysentery.
Intestinal flagellates are so common in the stools of well people in the tropics that one should be very careful in assigning a pathogenic rôle to them.
It is now generally accepted that Lamblia (Giardia) can bring about exhausting diarrhoeas.
Intestinal Myiases
In the tropics vague intestinal disturbances or violent abdominal cramping may be brought about by dipterous larvae in the intestinal canal. The symptoms may be those of a dysentery and may be attended with fever and malaise. The biliary tract also may be invaded. For a more detailed statement of the several myiases, see Chapter XXV.

Fig. 158.—Larva of Musca vomitoria (Calliphora vomitoria); below: of natural size; above, enlarged. (Leuckart.) (From Tyson.)
Fig. 159.—Larva of Anthomyia canicularis, enlarged. Rarely found in the stool. (Gould.) (From Tyson.)
The larvae usually obtain access to the alimentary tract in food taken in by the mouth. Flies of the genus Sarcophaga are prone to deposit their larvae on food, especially meat that is somewhat tainted. Other flies, as Musca or Anthomyia, may lay their eggs on food. Flies of the genus Anthomyia tend to lay their eggs on plants.
It is possible for a fly to deposit its eggs or larvae about the anus while the man is at stool.
Great care must always be observed to assure one’s self that fly larvae, which may be present in the stool, have not originated from larvae deposited on the stool subsequent to its passage.
Determination of Dipterous Larvae
There are certain points in the anatomy of dipterous larvae which must be considered in recognition of the genus or family of the flies concerned in the various myiases. The broad extremity is the posterior[591] one and the tapering one the anterior. The dark hook-like processes, which may be in pairs or fused, project from the anterior or head end and above them is a pair of projecting papillae. The second segment from the head has on either side projecting hand or fan-like structures with varying numbers of terminal divisions, 4 to 40 or more. These are the anterior spiracles.
The large terminal segment has on its posterior surface two chitinized plates with 3 slits of various architecture in each. These are the posterior stigmal plates and are the structures we pay particular attention to in identification. In the early larval stages there is only one slit; in the second stage there are two. It is only in the fully developed larval stage that we note the characteristic 3 slit stigmal plates. The presence or absence of a rounded protuberance or button at the base of each stigmal plate should be looked for. The area carrying the stigmal plates may be sunken to form a pit. (See Fig. 135.)
Key To Larvae of the Myiases. (Banks.)
| 1. | Body with lateral and dorsal spinose processes | Homalomyia. |
| Body without such processes | 2 | |
| 2. | Body ending in two fleshy processes; rather small species | 3 |
| Body truncate or broadly rounded at end | 4 | |
| 3. | Processes bearing the stigmal plates; body about 5 mm. long | Drosophila. |
| Processes not bearing the stigmal plates; body 10 mm. or longer | Piophila. | |
| 4. | But one great hook; posterior stigmal plates with winding slits; no distinct lateral fusiform areas; tip of body with few if any conical processes | Muscinae. |
| With two great hooks; slits in the stigmal plate not sinuous | 5 | |
| 5. | No tubercles about anal area; no distinct processes around stigmal field | 6 |
| Distinct tubercles above anal area; often processes around stigmal field; lateral fusiform areas usually distinct | 7 | |
| 6. | Stigmal plates on black tubercles; lateral fusiform areas distinct | Ortalidae. |
| Stigmal plates barely if at all elevated; lateral fusiform areas indistinct; stigmal plates often contiguous or nearly so; slits long and subparallel | Trypetidae. | |
| 7. | Slits in stigmal plates rather short, and arranged radiately | 8 |
| Slits slender and subparallel to each other | 9 | |
| 8. | Two tubercles above anal area; stigmal field with distinct processes around it | Anthomviidae. |
| Four or more tubercles above anal area; slits of stigmal plates usually pointed at one end | Muscinae. | |
| 9. | A button to each stigmal plate; slits rather transverse to body | Calliphorinae. |
| No button to stigmal plates, slits of one plate subparallel to those in opposite plate; plates at bottom of a pit | Sarcophagidae. |
A specimen of stool containing fly larvae may be incubated in a moist chamber in order to obtain the imago for species determination.
CHAPTER LI
THE JOINTS, BONES AND MUSCLES IN TROPICAL DIAGNOSIS
In considering the diagnostic significance of bone and joint manifestations of tropical diseases, it is essential that the practitioner in the tropics bear in mind the cosmopolitan arthropathies.
It should be remembered that lesions of joints may accompany or follow almost all infectious diseases, and that it is often impossible to ascertain if the lesions be due to the actual presence of organisms within the joint or to the action of toxic substances elaborated elsewhere; so that infectious arthritis is broadly defined as arising from the presence within the body of a focus of infection. This definition is further expanded to include joint affections of intestinal origin, and also those in which neither the causal organism nor its focus of origin is discoverable, but which by analogy we unhesitatingly recognize as being due to an infective agent.
It is to be noted that the lesions of arthritis may develop either in the intra-articular membranes or in the bony parts adjacent to a joint, and that they may remain confined to their primary site or eventually extend to involve other tissues.
Infectious Arthritis
A. Of known etiology.
May be acute or chronic. Examples are: Gonorrhoea, typhoid, tuberculosis, bacillary dysentery, pneumococcus infections, pyogenic cocci, filariasis, Malta fever, secondary to any recognized focus.
B. Of unknown etiology.
May be acute or chronic: Examples are: Acute articular rheumatism, rheumatoid arthritis, four types beginning with acute symptoms, one type having insidious onset. These are often due to unidentified foci.
Noninfectious Arthritis
A. Traumatic.
1. Acute, due to known traumatism.
2. Chronic, generally static in origin, or due to chronic strain or irritation. Possibly includes villous arthritis of the knee and hypertrophic arthritis in the young.
B. Trophic.
1. Metabolic. Examples are gout, psoriasis and probably hypertrophic arthritis.
2. Senile.
3. Neuropathic. Examples are tabes, leprosy, syringomyelia, Raynaud’s disease, and scleroderma.
4. Arteriosclerotic.
C. Blood dyscrasias, as haemophilia, anaemias and scurvy.
D. Toxic, as lead poisoning.
The diseases of more peculiar importance for the tropics in which joint involvement must be considered in the diagnosis are the following:
Malta Fever.—This infection offers a good example of a disease in which joint symptomatology is of diagnostic and therapeutic importance. A prolonged typhoid-like course with sudden and painful swelling of various joints, hip, shoulder, ankle or costo-vertebral articulations, if occurring in the endemic area of Malta fever, would at once make one suspect this disease. Typhoid does not give painful joints, dengue is not accompanied by joint swelling, while gonorrhoeal polyarthritis will be accompanied by other evidence of gonorrhoeal infection.
The neuralgias, sciaticas and painful joints, together with the sweats which exhaust the sufferer from Malta fever, often tempt both patient and physician to resort to narcotics. Acute or subacute effusion into one or more joints is present in at least 40 per cent of cases of Malta fever according to Rogers. The Malta fever joint is not red, which fact, taken with its evanescent character, differentiates it from the arthritis of acute rheumatic fever.
Dengue.—Sporadic dengue is difficult to diagnose. In an epidemic the characteristic pains referable to tendinous insertions about joints are present in at least 50 per cent of cases and is of great diagnostic value. There is no swelling of the joints although the turgescence of the skin over them may give the impression of an arthritis. The intensity of pain varies from a feeling of muscular soreness to excruciating pain when muscles or joints are actively moved. Passive movement is not usually painful. In addition to the rachialgia, bone and joint pains, some writers have described swelling of the joints. This in my experience is unusual. Joint pains are so characteristic that they distinguish dengue from all other eruptive fevers.
Joint pains during convalescence may produce stiffness and crippling continuing for many weeks after the cessation of fever.
Relapsing Fever.—Bone, muscle and joint pains are practically always present in this disease. In addition rachialgia and headache are prominent symptoms and the aching gnawing pains in loins or nape of neck may make one think of beginning smallpox, dengue or yellow fever. There is no swelling of the joints in relapsing fever. As in dengue the pains in the neighborhood of the joints may be quite persistent.
Yaws.—This disease gives us bone, joint and muscle lesions similar to those of syphilis. From the mother lesion to the tertiary framboesioma[594] the course and symptoms of the two diseases are similar. Thus we may have the flying pains and osteocopic pains of the early days of infection and, as later events, chronic synovitis, frambroesial infiltration of perisynovial membranes, frambroesial infiltration of synovial membranes, chondro-arthritis, epiphysitis and chronic frambroesial periostitis. These pathological processes cause such conditions as we know under the names dactylitis, saber shin, mutilating oro-rhino-palato-pharyngeal ulcerations, Parrot’s nodes and cranio-tabes.
The uncomplicated framboesioma must be pathologically similar to the gumma. Certainly the later effects of bone and joint destruction and scarring are wonderfully like some of the middle-age European descriptions “when lues was in flower.” In framboesial disease the damage from bone destruction or from contracture following cicatrization may be so complete as to render useless a finger, a hand, one of the large joints or even a whole extremity.
Bacillary Dysentery.—As far back as the 17th century (Sydenham) it was noted that joint pains or actual arthritides were occasional complications of dysentery. We now know that the bacterial types of dysentery are those most likely to show joint complications. Because the joint fluid in these lesions is usually sterile, it is assumed that they are the effect of toxins (or a toxin) produced by B. dysenteriae. Of the two hypothetical toxins of the dysentery bacillus one is supposed to produce neuritis and joint complications. Arthritides are more common in some epidemics than in others and with certain strains of bacilli than with others. The Shiga strain is the worst offender in this regard. Manson reports 27% of joint involvement in one epidemic.
Clinically, dysenteric arthritis is more apt to affect one of the larger joints, the knee, ankle and hip, being most affected. The elbow, wrist or shoulder joint may be affected, though this is unusual. The pain and swelling may be an incident of the early part of the attack. Usually it comes on when the acute symptoms are abating or as a sequela. The joint is distended with effusion and this involves the ligaments around the joint. Given an arthritis in the course of a frank dysentery there is nothing it could ordinarily be confused with. It is well to remember, however, that patients with dysentery may have also a concurrent gonorrhoea or arthritis from some focal infection. The dysenteric rheumatism ordinarily completely subsides with the cure of the colitis.
In hepatic abscess following amoebic colitis pain of some type is a frequent symptom. Rheumatic-like pains and swelling of the hands occur rarely, rapidly disappearing when the abscess is evacuated.
Filariasis.—Maitland and Bahr have noted a synovitis which is apparently a complication of filariasis. Bahr has found a fibrotic ankylosis[595] often to follow such a joint condition. The synovitis may be followed by pus formation with serious or fatal outcome.
Guinea Worm Disease.—Very rarely the female Dracunculus may penetrate a joint and cause synovitis or arthritis.
Leprosy.—Occasionally there is joint involvement, especially of the wrist and ankle joints, in which erosion of the cartilage and bone dislocation occur giving us a condition similar to the Charcot joint.
It will be remembered that the Charcot joint is most often seen in tabes and may give one of the greatest joint swellings. As a rule only one joint, usually knee or hip, is involved in tabes and the affection is generally painless. The progress may be acute, subacute or chronic. Syringomyelia, a disease which may be confused with leprosy, may also show joint involvement, usually of the upper extremity.
Bone Affections
Mycetoma.—As the result of the invasion of an extremity—usually the foot—with the causative fungi, disorganization of the tissues involved takes place. The granulomatous process invades muscles and bones and as a result of the sinus formation we have the bones converted into a softened, cheesy mass. This disintegration of bone and other tissues is attended with little or no pain. The granules discharging through the sinuses make for a proper diagnosis.
Goundou.—In goundou the nasal bones and the nasal processes of the superior maxilla are the seat of symmetrical swellings of the nature of an hypertrophic osteitis. These exostoses may be quite large so that there is interference with vision. There is little or no pain connected with the bony growths and there is no invasive tendency.
Big Heel.—There has been observed in natives of the Gold Coast an affection of the os calcis somewhat like that involving the superior maxillary bones in goundou. The disease begins with pain and tenderness of one or both heels. The enlargement may involve only one os calcis or affect both bones. There is no joint involvement but locomotion is interfered with. There are periods of improvement which are followed by return of the pains.
Ainhum.—In this disease there is thinning or absorption of the bones of the toe. A fibrous cord replaces the bony structures.
Oroya Fever.—In this very serious disease of certain areas of Peru the bone pains may be excruciating. These bone pains are especially marked in the sternum but also involve the long bones.
Trench Fever.—Pain over the shin bone is a prominent complaint in this affection so that the term “trench shin” has been employed.
Relapsing Fever.—Bone pains, especially referred to the knees, are complained of by patients with the bilious typhoid of Griesinger. This is a type of relapsing fever occurring in Egypt.
Leprosy.—The bone affections of leprosy are considered under the muscles.
Muscle Involvement
Leprosy.—In this ancient disease the course of which is marked by anaesthesia, atrophy, absorption and accidents (cigarette burns, etc.), the lesions of bones, joints, muscles and indeed of all other tissues are, in great part, due to infiltration of nerves by the organism of leprosy. The effects are secondary and trophic on the one hand, and on the other partly due to secondary infection of the leproma by various bacterial agents. Leprosy was for centuries confused with other diseases in which ulceration and mutilation are features. The value of mercury in differentiating syphilis, the recognition of the importance of anaesthesia in this disease, together with the discovery of the bacillus of leprosy and of the etiological factors of several other confusing diseases, have made of leprosy one of the easiest of all diseases to diagnose correctly. It is, however, essentially a laboratory diagnosis.
In nerve leprosy we often get atrophy of the small muscles of the hand and of the muscles of the forearm. The contracture which takes place under these circumstances gives the “claw hand.” In tubercular and mixed forms of leprosy we may get in addition trophic disturbances of the fingers and toes and also extraneous infections which may ultimately result in amputation of fingers or toes. This process, going on over a considerable time or being repeated, results often in stumping of fingers or hands or toes and feet.
In addition to these openly destructive processes there is often seen in leprosy a condition of subcutaneous absorption of all the tissues. In this way the distorted finger nail may come to occupy a seat over the knuckle or even (though rarely) further up the back of the hand or arm. Briefly in leprosy we have, as representing the pathology, muscular atrophy from nerve involvement, periostitis and arthritis, interstitial absorption of bone and contractures resulting in mutilation of fingers, toes, hands and feet from trophic disturbance and intercurrent bacterial infection.
Beriberi.—In this disease we have muscular atrophies, especially of the muscles innervated by the peroneal and ulnar nerves, similar to those following other forms of peripheral neuritis.
Amoebiasis.—There have been reported very rarely disintegrating lesions of muscles and cutaneous tissues in which amoebae have been found.
Heat Cramps.—In those working in firerooms or steel-mills, the excessive heat to which they are subjected may cause various manifestations of heat prostration, among which the painful muscle cramps are prominent. These cramps are similar to those which are such a feature of Asiatic cholera and in each instance are supposed to be the result of dehydration of muscle tissue.
Trichinosis.—Acute muscle pain is a feature of the stage of muscle penetration by the larval Trichinella spiralis. In the disease we have a fever suggestive of typhoid fever and oedema about the face. A marked eosinophilia is characteristic. Another helminthic parasite which may invade the muscles of man is the larval Taenia solium. This must be of extreme rarity because infection with the adult T. solium is most rare and it is only accidental that the embryonic stage would occur in man. It is a fact that the common tapeworm of man, Taenia saginata, is found in the human host only as a sexually mature parasite in the intestines; there is never a cysticercus stage in the muscles.
Myositis purulenta tropica.—We may have a suppurative myositis with a single abscess formation or with disseminated foci or a diffuse purulent infiltration. The attending fever and toxaemia are similar to those attending any deep abscess formation. Abscess formation in the muscles has been reported from various parts of the tropics, especially the Gold Coast. It is possible that F. bancrofti infections are concerned in some of these conditions.
Filariasis.—Filarial abscesses were found in the ilio-psoas muscles in four cases. Wise and Minett found evidences of adult filarial worms (F. bancrofti) in 22 out of 28 deep-seated abscesses, which were examined by them.
CHAPTER LII
NEUROLOGICAL CONSIDERATIONS IN TROPICAL DISEASES
There is a great tendency in the tropics to ascribe neurological manifestations to beriberi or malaria. It must be acknowledged, however, that various sensory and motor phenomena, which may show themselves from time to time, in those who have suffered from beriberi, are common and prove sources of confusion in diagnosis. Tropical sunlight with its ultra-violet rays had a vogue which held sway for a brief period as explaining most nervous conditions in Europeans in the tropics. At present we are inclined to believe that excesses in eating and drinking and late hours may be more potent in the production of nervous breakdowns than are factors less cosmopolitan.
While syphilis is rampant in many parts of the tropical world the usual views are that the luetic neurological manifestations, so common in temperate climates, are more or less nonexistent. At the same time it would seem advisable with this point in view to study the cases attributed to other causes along the line of laboratory investigations of the cerebro-spinal fluid.
Clinically there are many points of difference between syphilis as seen in the native races of tropical regions and as observed in Europeans at home, and it would seem advisable to do more work along the line of spinal fluid examinations. The examination of the spinal fluid for syphilis should include a Wassermann test using several concentrations ranging from 0.2 to 1.0 cc., a globulin estimation, cell count and Langes colloidal gold reaction,—the last not being necessary however, unless positive findings are obtained in one or more of the other tests. Of course the most important test is the Wassermann of the spinal fluid and every one should bear in mind the marked complement fixation power of the spinal fluid of paretics. In such a fluid we almost always obtain a positive reaction where quantities of 0.2 cc. or less are employed, while with locomotor ataxia or cerebro-spinal lues amounts of 0.5 to 1 cc. are generally required to give a positive test. It is not necessary to inactivate spinal fluid.
These tests can only be carried out in a well equipped laboratory and the same is true of the colloidal gold one. The tests for cell increase and globulin increase, however, can be made by anyone prepared to do ordinary clinical laboratory work.
The normal spinal fluid is as clear as water, has a specific gravity of about 1.010 and is under a pressure of about 5 to 7 mm. of mercury or 60 to 100 mm. of water. The sugar content is about 0.07% and the proteid content about 0.03 to 0.04%.
Cerebro-spinal Fluid Examinations
To withdraw spinal fluid for bacteriological examination or cytodiagnosis we use a sterile needle about 4 inches long for an adult, preparing the skin as described for blood cultures from a vein (see page 516). The patient is placed on the left side with knees drawn up and head and shoulders carried forward to give the greatest possible space between the spinous processes by arching the spine. A line at the level of the iliac crests passes between the third and fourth lumbar vertebrae. Select a point midway between the spinous processes of these lumbar vertebrae and enter the needle two-fifths of an inch to the right of this point, pushing the needle inward and upward. Collect the material in two or three sterile test tubes, to avoid contamination of the entire sample by a drop of blood which may come out in the first portion. The presence of blood in very slight amount interferes with cytodiagnosis and globulin tests and, if present in more than a trace, it makes the colloidal gold test practically worthless. Make cultures on blood serum at the earliest possible moment. Centrifugalize a portion of the fluid at high speed and examine the sediment for bacterial content. After the puncture the patient should drink a glass or so of water and remain in bed for a day, preferably with the head lower than the feet.
In general terms, excluding syphilis, it may be stated that:
1. A lymphocytosis indicates a tuberculous or poliomyelitis process. With these diseases, the fluid will probably be clear.
2. An abundance of polymorphonuclear and eosinophilic leucocytes indicates an infection with pyogenic organisms, in which cloudy fluid is the rule.
Meningism shows very few cells.
Trypanosomiasis gives a cellular increase very similar to syphilis. In the work of the French Sleeping Sickness Commission five cells per cubic millimeter was taken as normal.
Not only may trypanosomes be found in the spinal fluid, when they mark the setting in of the “sleeping sickness” stage of trypanosomiasis, but a case has been reported of the presence of Trichinella embryos in the spinal fluid. Recently a few cases have been reported of anthrax meningitis, in which anthrax bacilli have been found in the spinal fluid.
Cell Count.—A method of examination considered by neurologists as of differential diagnostic value is to count the number of cells in a cubic millimeter of the cerebro-spinal fluid. The technic is to use a gentian-violet-tinged 3% solution of acetic acid. This is drawn up to the mark 0.5, and the cerebro-spinal fluid is then sucked up to 11. After mixing, the cell count is made with the haemacytometer.
Count all the cells appearing in the entire ruled area (9 large squares) and add one-sixth of this number to find the approximate total number of cells per cubic millimeter of spinal fluid examined as above. It is advisable to make the cell count of the fluid as soon after obtaining it as possible, the cells tending to degenerate or adhere to the glass of the tube. The latter can be minimized by vigorous shaking before withdrawal of the fluid for counting. Normally we have only two to ten cells per cubic millimeter, but in tabes and general paresis this is increased to 50 or 100 cells, greatest at onset of disease.
Pleocytosis.—Miller gives the following table as to pleocytosis:—
Average Incidence of Lymphocytosis in the Spinal Fluid
(Plaut, Relim and Schottmuller)
| Clinical diagnosis | Frequency, per cent. |
Remarks |
| Cerebro-spinal lues | 85-90 | Counts often over 100—may reach 1000 per c.mm. |
| Tabes dorsalis | 90 | Counts usually under 100. |
| General paresis | 98 | Counts average 30-60 cells per c.mm. |
| Secondary lues | 30-40 | Moderate increase as a rule. |
| Multiple sclerosis | 25 | Border-line counts. |
| Cerebral haemorrhage | { Frequency | |
| Cerebral tumors | { is | Cellular increase is apt to be a very moderate one. |
| Sinus thrombosis | { variable | |
Globulin Increase Tests.—Noguchi’s butyric acid test is very satisfactory, but because of the objectionable odor of the butyric acid, we use the Ross-Jones and Pandy tests routinely in our laboratory.
For the Ross-Jones method, one cc. of saturated solution of ammonium sulphate is placed in a small test tube and one cc. of spinal fluid placed on top of this column. If globulin increase is present a turbid ring appears within a few seconds at the junction. Normally there is no sign of a ring. This test is a modification of Nonne’s Phase 1 reaction. For Pandy’s test, prepare a saturated solution of carbolic acid crystals in distilled water. Place 1 cc. of this reagent in a small test-tube and add 1 drop of spinal fluid. In a normal fluid, only the faintest opalescence is observed; but in a fluid with globulin increase a smoke-like white cloud develops instantly where the drop comes in contact with the reagent.
Colloidal Gold Test (Lange’s).—It is now generally accepted that this test is more diagnostic of general paresis than any other single test.[601] The color changes in the first five tubes (1-10 : 1-160) are so constant that the term “paretic curve” is applied to such findings. Of less diagnostic value are the so-called cerebro-spinal lues curves where the color changes, though of less intensity than the paretic ones, are most marked in the third, fourth, fifth and sixth tubes (1-40 to 1-320). In various types of meningitis, other than luetic, the color changes are at times more marked in the tubes with the higher dilutions of spinal fluids (from 1-320 to 1-2560).
The paretic curve of the colloidal gold test generally runs parallel with a spinal fluid Wassermann and globulin increase. This agreement does not exist at all constantly for positive blood serum Wassermann tests and increased cell counts.
It may be stated that this test is of more importance in paresis than any single one of the four reactions of Nonne, viz.: (a) blood serum Wassermann; (b) spinal fluid Wasserman; (c) globulin increase, and (d) increased cell count of spinal fluid (pleocytosis). Of course, all of these tests should be carried out.
Test.—The test is carried out by preparing a series of ten test tubes containing dilutions of spinal fluid in 1 cc. of normal saline, ranging from 1-10 to 1-5120, and adding 5 cc. of the colloidal gold reagent to each tube and to a control tube containing salt solution alone. The successful application of the test is dependent upon (a) care in the preparation of the reagent; (b) absolute cleanliness of all glassware used, and, (c) on the entire absence of blood from the spinal fluid. Before using a new colloidal gold solution, it should be tested with spinal fluid of known reaction, so that it may be discarded if too sensitive or not sufficiently so. The color changes usually start almost immediately and if there is no change evident in half an hour, there will probably be none later. The maximum change occurs after several hours, so that readings are made after the tubes have stood overnight at room temperature. The proper color of the control in tube 11 should be salmon-red or old rose and the fluid should be perfectly transparent. When the color is changed in tubes containing dilutions of the spinal fluid we record one showing a bluish tint as 1. When the change is to a lilac we record it as 2. A distinct blue is marked as 3 and a pale blue as 4. When decolorization is complete there is the highest color change, which is noted as 5.
Mastic Test.—The mastic test as devised by Cutting is apparently of value as an aid in the diagnosis of syphilis of the nervous system. The test is made by treating six dilutions of spinal fluid in test tubes with an alcoholic extract of pure gum mastic, diluted with distilled water before using. Its great value lies in the ease of preparation from an effective gum mastic, and in the keeping qualities of the stock alcoholic extract. After standing at room temperature for twelve to eighteen hours or at 37°C., for six to twelve hours, readings are made. In positive cases (paresis) the mastic will be precipitated in the first one, two, three or four tubes (higher in strongly positive cases) leaving the supernatant fluid clear, with the mastic as a white flocculent precipitate at the bottom of the tube. In some positive reactions the opalescence of the fluid persists with a fine white precipitate at the bottom. The control tube must remain unchanged.
Showing the Average Frequency of the Various Reactions in Syphilis Of The Central Nervous System (Miller)
| Paresis | Tabes dorsalis | Cerebro-spinal | |
| per cent. | per cent. | syphilis | |
| Blood Wassermann | 98-100 | 70 | 70-80 |
| Spinal fluid Wassermann | 97 | 60-80 | 85-90 |
| Pleocytosis | 98 | 85-90 | 85-90 |
| Positive globulin test | 100 | 90-95 | 90-95 |
| Colloidal gold test | 98-100 | 85-90 | 75-80 |
| Paretic curves | Luetic type of curve | Luetic curve | |
Other Chemical Constituents.—Normally the fluid reduces Fehling’s or Benedict’s qualitative copper solutions. It is well for one to gain experience with the degree of reduction to be normally expected as the test is but slightly marked. Quantitatively, the reducing substance is equivalent to 60-70 mg. glucose per 100 cc.
The urea is practically the same as in the blood, parallels any change in the latter, and has the same significance. Creatinine is about half that of the blood, and has apparently no clinical significance. Uric acid is present in still smaller proportion.
Delirium and Coma
It is difficult to make a sharp distinction between a disease showing delirium and one showing coma as delirious states tend to be followed by coma or such conditions may alternate.
In yellow fever the alert, suspicious mental state may give way to one of marked delirium requiring close watching to prevent the patient throwing himself from his bed.
In plague there is more of a mild delirious state in which the patient has a great tendency to wander about. The mental state is rather that of an intoxicated person with the thickness of speech and retardation of mental processes.
Typhus fever and spotted fever of the Rocky Mountains tend to produce stuporous states.
A delirious state, especially at night, is often noted in tsutsugamushi.
Rat bite fever also tends to show delirium.
In the ordinary paroxysm of malignant tertian there is quite a tendency to flightiness during the prolonged hot stage. In the cerebral types of pernicious malaria there may be violent delirium followed by[603] coma or the patient may be comatose from the onset of the paroxysm. Such conditions are often mistaken for sun stroke. In the comatose form of malaria we have a high temperature with sighing or stertorous breathing and at times Cheyne-Stokes respiration.
Following upon the algid stage of cholera we may have a stage of reaction without the disappearance of anuria, in which a typhoid state, with low muttering delirium or even with an acute delirious state, supervenes.
Toward the end of the sleeping sickness stage of trypanosomiasis we have a subnormal temperature with a comatose state.
Comatose states following upon the acute confusional psychoses of pellagra are not uncommon. Pellagra may show an acute collapse delirium.
In heat stroke we may have either delirium or coma. There is no more difficult problem encountered in the tropics than the one of differentiating cerebral malaria from heat stroke.
Oroya fever is frequently accompanied by delirium.
In typhus fever (tabardillo) delirious or stuporous states are to be expected about the end of the first week or even earlier. This is a disease in which the clouding of the consciousness is almost as marked as in plague. Delirium is more apt to occur at night.
In very toxic cases of bacillary dysentery there may be a mild delirium.
Insomnia.—Sleeplessness or, at any rate, a condition where the patient only dozes is often seen in dengue. This mental alertness and wakefulness may also be noted in yellow fever. In malaria, possibly connected with quinine administration, we may have marked insomnia although cases have been reported of insomnia due to malaria which has been relieved by quinine.
Just as cardiac decompensation from any cause will be attended by a distressing insomnia so is this also a feature of beriberi where cardiac involvement is marked.
Liver abscess may be attended with insomnia.
Malta fever is often attended with a weariness from suffering with the various joint and nerve pains so that insomnia is often marked.
Even in trypanosomiasis insomnia may be present at first. Insomnia is also one of the early neurasthenic manifestations of pellagra.
Somnolence.—The disease in which this symptom is best known is sleeping sickness. The patient may go to sleep lying in the bright sunlight or in the midst of eating a morsel of food. These cases can[604] be easily aroused but quickly drop off to sleep afterwards. They often deny that they were asleep. Later on in sleeping sickness the patient may sleep from 24 to 36 hours continuously and a more marked tendency to somnolence may be present by day than by night.
In the prodromal stage of leprosy somnolence is often marked and accompanied by a sensation of unaccountable weakness. Sweatings and accessions of fever may also be noted at this time.
In plague the rather stuporous state of the patient may give the impression of somnolence.
Cephalalgia, Rachialgia and Other Pains
Yellow fever is marked by pains in the lumbar region, the coup de barre of the French. It is as if the patient had been beaten over the small of the back with a bar of iron. The headache is rather orbital and is often excruciating. There are also frequently heavy, dull pains of the extremities.
Blackwater fever also has marked pains in the lumbar region giving expression to the kidney damage done by the haemoglobin detritus plugging the tubules.
In all forms of malaria, but especially in the paroxysms of malignant malaria, there are severe headaches and pains in the extremities. Intermittent neuralgia is often regarded as malarial.
Dengue gives rise to a marked post-orbital soreness rather than pain. There is also a marked rachialgia with pains in the limbs often referred to the regions of the joints, which, however, are not swollen.
In Malta fever the neuralgias, especially sciatica, often associated with suddenly appearing, painful joint swellings, are prominent features.
In trypanosomiasis headache is often marked, together with a characteristic deep hyperaesthesia, so that the striking of a limb against a hard object gives rise to excruciating pain, there being, however, a delay in the experiencing of the painful sensation.
In relapsing fever the headache is often intense with pains in the back and bones.
In cholera one of the most striking phenomena of the disease is the terrible cramping of the muscles, especially those of the calves and feet. These pains actually torture the patient. Cramps of abdominal muscles as well as those of extremities are often noted in heat stroke in men in firerooms.
In beriberi there is often pain in the epigastric region so that the slightest touch causes great distress. This epigastric tenderness is[605] also a feature of yellow fever. The calf muscles are also markedly hyperaesthetic in beriberi.
In leprosy the neuralgic pains may be very severe while the nerves are being pressed upon by the connective tissue increase of the endoneurium and perineurium. Mention has been made of excruciating pains of toes, especially the big toe, even suggesting gout.
The excruciating pains of Oroya fever are connected with the changes taking place in the bone marrow. There is probably more rapid alteration in the blood picture in this disease than in any other. It might be designated a fulminating pernicious anaemia.
Pain on pressure on dorsal or lumbar spine is common in pellagra.
Plague may be associated, during the first day or two, with an excruciating headache. This may even be prodromal but tends to disappear with the rapidly developing stuporous state of the patient.
In typhus fever boring headache, oppressive rather than lancinating, is a feature of the first days. It is usually frontal or temporal.
In malignant tertian the headache is often quite intense during the prolonged hot stage. The headache of malaria is usually frontal or suboccipital.
In trench fever we may have a cutaneous hyperaesthesia over the shins. Rocky Mountain fever shows joint pains.
Tremors and Convulsions
It is in trypanosomiasis that we have the most important tremor. It is the fine tremors, which first are noticeable in the tongue and later in hands and even legs, that mark the onset of the stage of sleeping sickness with the trypanosomes in the cerebro-spinal fluid. At times an intention tremor may be noted in advanced cases of sleeping sickness. In addition we have epileptiform seizures in sleeping sickness.
In cerebral manifestations of pernicious malaria there is a type characterized by epileptiform convulsions.
In the acute stage of Brazilian trypanosomiasis we may have almost any type of cerebral or cord lesion.
Tremors of tongue and hands may be present in the second stage of pellagra.
Fibrillary tremors have been noted in the main-en-griffe of beriberi but tremors of the tongue and hands, so common in alcoholic neuritis, are rare in beriberi.
Convulsive seizures are not uncommon in the hyperpyrexial type of heat stroke.
In infantile beriberi the child often becomes rigid. There is not a true convulsion but such cases are at times thought to have meningitis.
In schistosomiasis and paragonomiasis as well as in infections with the larval stage of Taenia solium we may have brain involvement and manifestations of Jacksonian epilepsy.
Altered Reflexes Including Sensory and Motor Disturbances
Beriberi.—It is usually stated that the tendon reflexes of the lower extremity, especially the patellar reflex, are absent. While this is generally true they may at first show an exaggeration and some cases do not seem to show any decided change. There may be striking variation from day to day in the reflexes. The superficial reflexes, especially the cremasteric, are as a rule more active than normally.
The sensory changes in beriberi are less marked than those of the motor side. There is rarely complete anaesthesia but rather a blunting of sensation. Hyperaesthesia, particularly of the muscles of the calf of the leg, is well marked when the muscles are grasped with the hand.
The anaesthesia is earliest noted over the shin bone and dorsum of the foot. A loss of tactile sense is often noted about finger tips making it difficult for the patient to button his coat.
The most striking motor phenomena are the foot and wrist-drop, especially the former. The extensor muscles are more markedly involved than the flexors. There is marked muscular weakness of foot as well as hands. The weakness of the muscles of the leg is often the first symptom to be complained of. The type of palsy in beriberi is mainly paraplegic although hemiplegic and monoplegic types have been reported. The paralysis of the diaphragm is the most serious of the muscle palsies.
Contractures of the muscles of the foot or calf of the leg may occur. Contractures of the muscles of the upper extremity are more rare. Muscular atrophy of the leg muscles is often marked. In the upper extremity the muscles of the hand are most frequently atrophied.
Pellagra.—There is considerable variation from time to time in the reflexes. Some authorities attach diagnostic value to the appearance of an exaggerated reflex on one side and a diminution or absence of the corresponding reflex on the other side. Ankle clonus may be present.
Paraesthesias and in particular a burning sensation of the erythematous areas are often noted. Hyperaesthesia of the dorsal and lumbar regions is often noted. Pruritus is at times complained of in the region of the perineum. We have muscular weakness.
Sleeping Sickness.—The deep reflexes are usually exaggerated and the superficial ones diminished or absent.
There is no distinct alteration of motor or sensory function except that of deep hyperaesthesia (Kérandel’s sign). There is usually marked weakness of muscles of locomotion.
Leprosy.—The usual statement is that there is an exaggeration of the deep reflexes. Ankle clonus has been rarely reported.
Anaesthesia is the most important symptom in the diagnosis of leprosy. This loss of sensation is often for pain and temperature with retention of tactile sense (dissociation of sensation—a prominent symptom of syringomyelia). The anaesthesia is not only found in the spots but associated with the leprous neuritis which chiefly involves the ulnar, facial and peroneal nerves. Muscle palsies and atrophies are common and the main-en-griffe appearance of the hand is seen.
In lathryism we have spasticity and an exaggeration of the reflexes.
A very remarkable disease called kubisagari or paralytic vertigo has been observed in Japan. This disease is thought to affect those living in stables. The attacks only last a few minutes and at other times the patient seems normal. An attack shows ptosis and diplopia, speech disturbances and palsy of muscles of back of neck, causing the head to fall forward. There may also be some paresis of muscles of extremities. The disease is not fatal. Cases have been observed in Switzerland.
The Gait
There are no gaits in tropical diseases which can strictly speaking be regarded as special types of gait. In beriberi we often note the designation tripod gait of beriberi. This simply refers to the manner in which a case of the paraplegic type of beriberi uses a stick held by his hands to assist him in dragging along his atrophied and enfeebled legs. The legs are widely separated and the stick placed in front makes the two legs and stick resemble a tripod.
It is true that beriberics show the steppage gait of multiple neuritis as, owing to more or less foot-drop and lack of power to extend the toes, the patient lifts his foot high from the ground to avoid scraping the toes, and bends to the other side. It is as if a man were walking through a mire.
When other groups of muscles than the foot extensor ones become involved the gait is that of extreme weakness—a shuffling one.
In sleeping sickness it is a shuffling gait. It is as if one were dragging the feet along from pure muscular weakness.
In pellagra we may see a gait in which the patient separates his legs rather widely and uses a stick in front, shuffling his feet along with knees slightly bent and soles of the feet scarcely raised from the ground.
Some cases show a typical spastic paralytic gait.
We often note under dengue the designation dandyfied gait. This refers to the stilted, mincing gait of a dandy and is probably the explanation of the derivation of the word dengue. The pains about the site of the insertions of muscles with the slightest movement make these patients walk in a stiff, self-conscious manner.
Psychic and Neurasthenic States
A very remarkable fact is that in many tropical and subtropical regions where syphilis is rampant among the natives there is slight or absent incidence of general paresis and locomotor ataxia.
Jefferys and Maxwell state that the parasyphilitic manifestations were absent in thousands of cases observed by them in Formosa. In the Philippines one sees occasionally typical cases of these parasyphilitic diseases but of course standard methods of treatment of syphilis have been employed there for many years.
In China, where there is practically no treatment for syphilis, luetic ulcerations are exceedingly common and it has been suggested that insufficient treatment cures the skin lesions but adds to the effects on the nervous system. It will be remembered that skin and nerve tissue arise from similar embryological layers (epiblast) hence a suppression of toxic effect on one tissue may add to the burden on the other. It has been suggested that if the surface lesions are allowed to develop to maturity, the skin, which is the great elaborating center for antibodies, will produce enough adequately to protect the whole body; whereas, if the surface lesions are aborted, there is a diminished stimulus with consequent diminished elaboration of protective bodies. The brain is then liable to parenchymal invasion, since chemicals, owing to difference in their physical properties, cannot replace natural antibodies in controlling the disease in this location. This theory takes no reckoning of differences exhibited by variant strains of treponema in their tendencies toward selective localization. It has been noted that the form of syphilis endemic in certain regions is much less virulent than is the cosmopolitan form.
Pellagra.—Very important in diagnosis is a more or less prolonged prodromal period of neurasthenia which is apt to be more marked in the winter at a time when the skin and alimentary tract manifestations are in abeyance. Along with the anxiety and unrest of this neurasthenia we have lack of mental concentration and depression of spirits.
A melancholic state is almost always present in the psychosis of pellagra. There is not the indifferent, satisfied, more or less happy mental state of the case of general paresis. Some consider the pellagrous psychosis to belong to the toxic group, as from alcohol or cocaine, while others place it in the group of infective psychoses, as the post-influenzal one. Gregor regards it as belonging to the infective-exhaustive group. The insanity of pellagra is that of an acute confusional one.
In the final cachexia there is a dementia.
Sleeping Sickness.—It may be many months or even years before the mental changes follow the trypanosome fever stage. At first[609] a change in disposition is noted, the patient becoming listless and apathetic.
There is great impairment of mental concentration and memory. There may be later on catatonic manifestations as echolalia, mutism or flexibilitas cerea. There may at times be paranoid manifestations to be succeeded by states of profound melancholia. In the terminal stage a comatose state overshadows the psychical manifestations.
Malaria.—Leaving out of account the acute delirious states which accompany cerebral malaria there have been reported cases showing various manifestations of psychic disturbances even to maniacal or melancholic forms of insanity.
It is a common practice to attribute the irritability and lack of mental concentration of those who have lived for a long time in the tropics to the damage done the cerebral cortex by the malarial parasite. It is certainly more reasonable to attribute these minor psychic disturbances to malaria rather than to actinic rays of the sun.
There is no doubt but that quinine, given either for treatment or prophylaxis of malaria, is a cause as potent as alcohol and tobacco in tropical neurasthenia.
Insolation.—It is popular to assign neurasthenic manifestations to the actinic rays of the sun or the tropical heat, as these influences operate on every resident of the tropics. It is very necessary to exclude derangements of the digestion due to errors in diet with resulting exhaustion of the pancreatic and hepatic functions.
Alcohol is a potent factor for tropical neurasthenia as the tendency is for excess in this direction in those who in temperate climates are only moderate drinkers.
Hookworm Disease.—The patients with this disease are apt to become hypochondriacal and even melancholic.
There is a correspondence between the physical and mental backwardness of children with this disease, a child of twelve, who by the Binet-Simon test will only be rated at 7 will also not seem larger or better developed physically than a child of seven years would be.
Malta Fever.—Owing to the neuralgic pains and insomnia patients with this disease are apt to become neurasthenic. They are peculiarly liable to form the morphine habit if this drug be placed in their hands for the relief of pain.
The victims of leprosy not only may show an indifference to their condition but may also exhibit a moral apathy.
Dengue often shows a rather marked neurasthenia during convalescence and this may be protracted if the patient tries to resume his active duties before his complete recovery.
In latah there is echolalia and echopraxia, the patient repeating words he hears and mimicking movements he sees. The mind is usually clear. As a matter of fact the symptoms show similarity to those of the catatonic form of dementia praecox. The disease is more common in that part of the world centering in the Malay peninsula. Suggestion is an important factor in this neurosis.
In amok, a sort of epileptiform seizure in which the patient is obsessed with a desire to kill, there may be no recollection of the running amok. After the attack the patient may be stuporous.
Lunacy in the Tropics
Van Loon, having examined over 200 cases from among 1100 insane patients in Java, found the most common types of mental disease to be dementia praecox, general paresis, various manifestations of cerebral syphilis and acute maniacal or confusional states. Not only were all forms of mental disorder known in European countries represented, but their comparative frequency and the types of conduct exhibited were, on the whole, what might be expected in the study of a group of similar cases encountered in any other part of the world.
Overbeck-Wright in his book—“Lunacy in India”—notes that 44% of cases were under treatment for various types of mania, 15.9% for melancholia, 4.8% for delusional insanity, 5.2% for idiocy, 5.7% for dementia and 6.6% for insanity following the use of Cannabis indica. It is noted that dementia praecox is not included in the statistical returns, but the author states that in his experience hebephrenia and katatonia account for a much larger proportion of cases than melancholia.
Overbeck-Wright is of the opinion that general paresis is quite common in India notwithstanding the fact that for many years the opinion has obtained that syphilis of the central nervous system and the parasyphilitic diseases were exceedingly rare among tropical natives. He regards the incidence of cerebral disease in syphilitic natives as less than with Europeans, attributing this fact to the existence of an immunity acquired through the prevalence of syphilis among these people during a period of several centuries. Cases of general paresis are generally reported under the diagnosis of chronic mania.
Van Loon also notes the mistake made in most books on tropical medicine as to the rarity of general paresis. General paresis being a disease in which we have such characteristic laboratory diagnostic tests, especially the colloidal gold test, there should be little difficulty in settling this question of its absence or relative infrequency among natives of tropical regions.
INDEX
- Acanthocheilonema perstans, 339
- Acidosis, 525
- in blackwater, 58
- in cholera, 236
- in heat stroke, 468
- in kala-azar, 131
- Aedes calopus, 105, 433
- Agglutination tests, 517
- in blood transfusion, 521
- in cholera, 230
- in dysentery, 184
- in Malta fever, 244
- Ainhum, 471, 595
- Alastrim, 486
- Albumin tests, 570
- Albuminuria, 574
- in blackwater, 61
- in malaria, 39
- in yellow fever, 110, 574
- Alcohol, and neuritis, 270, 287
- and liver abscess, 167
- Alimentary tract, 586
- American leishmaniasis, 138
- Amoebae, 148, 158, 159
- Amoebic dysentery, 147
- Amok, 610
- Anaemia, 553
- Ancylostomiasis, 319, 493, 546, 548, 554, 563, 567, 609
- ancylostoma in, 320
- diagnosis in, 329
- epidemiology of, 323
- geographical distribution of, 320
- ground itch in, 328
- history of, 319
- life history of hookworm, 321
- pathology of, 324
- prognosis in, 331
- prophylaxis in, 331
- symptomatology of, 326
- Ancylostomiasis, symptoms in detail of, 328
- treatment of, 332
- Anopheline mosquitoes, 18, 20, 24
- Antimony, administration of, 134
- Arsenic and beriberi, 270
- Arsphenamine, administration of, 96
- Arthritis, infectious, 592
- noninfectious, 592
- Aspergillus fumigatus, 474
- Atriplicism, 556
- Aural myiasis, 568
- Bacillus alkaligines faecalis, infection with, 485
- dysenteriae, 175
- icteroides, 101
- leprae, 248
- pestis, 190
- Bacterium tularense, 214
- Balch’s staining method, 513
- Basal metabolism, 489
- Benign malaria, 29
- Beriberi, 268, 492, 547, 555, 596
- acute pernicious, 282
- and scurvy, 286
- asylum, 279
- atrophic, 280
- definition of, 268
- diagnosis in, 285
- endocrine gland disturbances and, 274
- epidemic dropsy, 278
- epidemiology of, 276
- etiology of, 269
- food deficiency, 270
- geographical distribution of, 269
- history of, 268
- infantile, 279, 287, 547
- paraplegic, 282
- [612]pathology of, 277
- Beriberi, polyneuritis gallinarum and, 275
- prognosis in, 288
- prophylaxis in, 288
- rice in, 272
- rudimentary, 280, 282
- ship, 285, 547
- symptomatology of, 278
- symptoms in detail of, 284
- synonyms for, 268
- treatment of, 290
- types of, 280
- vitamines in, 271, 275
- wet, 280
- Berne, 421
- Big heel, 595
- Bilharziasis, 357, 360
- Bilious remittent malaria, 34
- Bilious typhoid of Egypt, 92, 111
- Black death, 188
- Blackwater fever, 55, 498, 541, 547, 553, 557, 560, 572, 574, 579
- complications in, 60
- definition of, 55
- diagnosis in, 61
- epidemiology of, 58
- etiology of, 57
- geographical distribution of, 56
- history of, 55
- pathology of, 59
- prognosis in, 64
- prophylaxis in, 64
- symptomatology of, 59
- symptoms in detail of, 61
- synonyms for, 55
- treatment of, 64
- Blastomycosis, 474
- Blood, chemical analysis of, 530, 576
- groups of, 521
- specific gravity of, 538
- transfusion of, 521
- Blood examinations, 504
- acidosis in, 525
- coagulation rate in, 537
- counting cells in, 507, 508
- culturing in, 516
- differential count in, 514
- Blood examinations, dried smears, 509
- fresh preparations in, 509
- haemoglobin in, 519
- in blackwater, 541
- in malaria, 39, 539
- in kala-azar, 131, 543
- staining films, 509, 512
- thick films in, 511
- wet preparations in, 509
- Blood in tropical diseases, 504, 538
- blackwater fever, 541
- filariasis, 544
- kala-azar, 543
- liver abscess, 542
- malaria, 539
- Malta fever, 541
- plague, 542
- relapsing fever, 544
- trypanosomiasis, 543
- typhus fever, 546
- Weil’s disease, 544
- Boils, tropical, 420
- Bone affections, 595
- Brazilian trypanosomiasis, 80, 501, 548
- diagnosis of, 84
- epidemiology of, 81
- etiology of, 80
- prophylaxis in, 84
- symptomatology of, 83
- transmission of, 81
- treatment of, 84
- types of, 83
- Bronchial spirochaetosis, 550
- Bronchomoniliasis, 474
- pulmonary tuberculosis and, 474
- Bubas, 138, 564
- Calabar swellings, 354, 556
- Carriers, in cholera, 225
- in dysentery, 153, 178
- in malaria, 24, 47
- Cephalalgia, 604
- Cerebro-spinal fluid, 598
- Chaulmoogra oil, 266
- Chenopodium, 163, 334
- Cholera, 218, 492, 547, 579, 597
- [613]agglutination in, 230
- Cholera, autopsy findings in, 227
- blood transfusion, 235
- carriers in, 225
- definition of, 218
- diagnosis in, 230
- disinfection in, 233
- epidemiology of, 222
- etiology of, 220
- geographical distribution of, 219
- history of, 218
- pathology of, 226
- prognosis in, 232
- prophylaxis in, 233
- sequelae in, 229
- serum in, 236
- symptomatology of, 227
- symptoms in detail of, 229
- treatment of, 235
- vaccination in, 234
- water transmission, 223
- Cholera red reaction, 232
- Cholerine, 229
- Chrysomyia macellaria, 422, 551, 568
- Chyluria, 346, 575
- Circulatory system, 547
- Climatic bubo, 469, 552
- diagnosis in, 470
- symptomatology of, 470
- Climatic fevers, 501
- Clonorchiosis, 371
- symptomatology of, 372
- Clonorchis endemicus, 372
- Coagulation rate, 537
- Coccidioidal granuloma, 474
- pulmonary tuberculosis and, 474
- Coccidioides immitis, 474
- Cochin China diarrhoea, 312, 374
- Colloidal gold test, 600
- Colon bacillus infection, 484
- Color index, 520
- Coma, 602
- Conorhinus rubrifasciatus, 123
- megistus, 80
- Convulsions, 605
- Cosmopolitan diseases, 480
- Craw-craw, 424
- Creeping eruption, 422
- Cryptococcus gilchristi, 474
- Culex fatigans, 432, 342
- Culicine mosquitoes, 20
- Culturing blood, 516
- Cutaneous system, 561
- Cyclops, 356
- Danysz’s virus, 210
- Delirium, 602
- Dengue, 431, 495, 545, 563, 593, 608, 609
- clinical types, 435
- definition of, 431
- diagnosis in, 436
- epidemiology of, 432
- etiology of, 432
- geographical distribution of, 432
- history of, 431
- mosquitoes in, 432
- pathology of, 434
- prophylaxis in, 438
- spirochaetes in, 432
- symptomatology of, 434
- symptoms in detail of, 436
- synonyms for, 431
- treatment of, 438
- Dengue-like fevers, 438
- Dermatobia cyaniventris, 421
- Dermatophiliasis, 418
- Dhobie itch, 414
- Diagnosis in tropics, 477
- Diarrhoea, 589
- Diphtheria, 487
- Dracunculus medinensis, 339, 355
- Dysentery, 141
- bacterial, 145, 174
- ciliate, 143
- definition of, 141
- etiology of, 142, 148, 175
- flagellate, 142
- from animal parasites, 142
- from poisons, 146
- helminthic, 145
- protozoal, 142
- Dysentery, (amoebic), 147, 492, 554, 596
- Charcot-Leyden crystals in, 157
- [614]complications in, 155
- diagnosis in, 156
- epidemiology of, 153
- etiology of, 148
- geographical distribution of, 148
- history of, 147
- pathology of, 154
- prophylaxis in, 160
- symptomatology of, 154
- transmission of, 153
- treatment of, 160
- Dysentery (bacillary), 145, 174, 501, 545, 548, 567, 594, 603
- chronic, 182
- collapse types, 181
- complications in, 181
- diagnosis in, 182
- epidemiology of, 177
- etiology of, 175
- gangrenous, 181
- geographical distribution of, 174
- history of, 174
- pathology of, 179
- prophylaxis in, 185
- symptomatology of, 180
- treatment in, 186
- vaccination against, 185
- Ear diseases, 568
- Ekiri, 145
- Elephantiasis, 347
- of scrotum, 348
- Emetine, 160, 171, 318
- Endemic haematuria, 363
- Endocrine disturbances, 489
- Entamoeba coli, 149, 150
- histolytica, 142, 148, 164
- tetragena, 149
- Eosinophilia, 533
- Epidemic dropsy, 278
- gangrenous rectitis, 589
- Epistaxis, 569
- Espundia, 138, 564
- Eye diseases, 565
- Faeces, 581
- intestinal parasites, 583
- occult blood in, 582
- ova in, 583
- Fasciolopsis buski, 373
- Fever-free diseases, 491
- Filaria bancrofti, 337, 341
- Filariasis, 336, 493, 544, 550, 552, 564, 566, 575, 594, 597
- abscesses in, 346
- and chylous hydrocele, 351
- chyluria, 346, 575
- clinical types, 344
- diagnosis in, 351
- elephantiasis, 347
- elephantoid fever, 345, 493
- etiology of, 337
- history of, 339
- life history of F. bancrofti, 342
- mosquitoes in, 342
- orchitis in, 347
- pathology of, 343
- scrotum in, 345
- varicose groin glands in, 345
- Flagellate dysentery, 142
- Flagellated body, 8
- Fleas in leishmaniasis, 124
- in plague, 192
- Focal infections, 490
- Framboesia, 384
- Funiculitis, endemic, 346, 580
- Gaits, 607
- Gametes in malaria, 8
- Gangosa, 395, 550, 569
- and yaws, 395
- diagnosis in, 398
- epidemiology of, 397
- etiology of, 395
- geographical distribution of, 395
- history of, 395
- pathology of, 397
- symptomatology of, 397
- treatment of, 398
- Genito-urinary system, 570, 579
- Giardia, 142
- Giemsa’s stain, 514
- Glanders, 487
- Glandular fever, 536
- involvements, 551
- [615]Globulin increase, 600
- Glossina morsitans, 67, 71
- palpalis, 66, 69
- Goundou, 472, 569, 595
- Granuloma venereum, 404
- diagnosis in, 406
- etiology of, 404
- history of, 404
- pathology of, 404
- symptomatology of, 405
- Guha, 551
- Guinea worm, 339, 340, 355, 595
- Haemacytometry, 505
- Haematoxylin staining, 514
- Haematuria, 575
- Haemoglobin estimations, 519
- Haemoglobinuria, 574
- haemoglobinuric fever, 55
- paroxysmal, 61, 574
- Haemolysis, test for, 521
- Haemorrhages, 554
- Haemosporidia, 4
- Haffkine’s plague prophylactic, 211
- cholera vaccine, 234
- Heat prostration, 464, 467, 494
- cramps, 467, 597
- stroke, 464, 501, 550, 573, 603
- etiology of, 464
- susceptibility to, 466
- symptomatology of, 466
- treatment of, 467
- Hill diarrhoea, 316
- Hirudiniasis, 559
- Hosts, 9
- Impetigo, 419
- Index of malaria, 9
- Infantile beriberi, 279
- scurvy, 287
- Influenza, 488
- Insolation, 464, 609
- Insomnia, 603
- Intestinal bacteria, 177
- parasites, 503, 583
- tract, 589
- Jansky’s blood grouping, 515
- Jaundice, 557
- epidemic, 114
- Jaundice, infectious, 114, 503, 544, 558
- cultivation of Leptospira icterohaemorrhagiae, 115
- definition of, 114
- diagnosis in, 117
- epidemiology of, 116
- etiology of, 115
- geographical distribution of, 114
- history of, 114
- pathology of, 116
- prophylaxis in, 117
- symptomatology of, 116
- synonyms for, 114
- treatment of, 117
- Joint involvement in tropical diseases, 592
- Juxta-articular nodules, 472, 564
- Kaffir milk-pox, 486
- Kala-azar, 121, 127, 498, 543, 552, 554, 558, 560, 563
- diagnosis in, 131
- epidemiology of, 127
- etiology of, 123
- history of, 121
- pathology of, 128
- prognosis in, 133
- prophylaxis in, 133
- symptomatology of, 128
- symptoms in detail of, 130
- synonyms for, 121
- treatment of, 133
- Katayama disease, 364, 550, 556
- Kidney function and its determination, 575
- Kubisagari, 607
- Lamblia, 142
- Lamus megistus, 81
- Large mononuclear increase, 536
- Latah, 610
- Latent malaria, 35
- Lathyrism, 288, 607
- [616]Laverania, 5
- Leishmania donovani, 123, 127
- infantum, 123, 127
- tropica, 123
- Leishmaniases, 121
- American, 138, 553, 564
- canine, 123
- cutaneous, 135, 564
- infantile, 130
- post-antimonial, 564
- relationship, 126
- visceral, 127
- Leishmanoid, dermal, 564
- Leishman’s staining method, 513
- Leprosy, 246, 492, 539, 555, 562, 565, 569, 580, 595, 596, 605, 607, 609
- bible and, 247
- cultivation of bacillus, 249
- definition of, 246
- diagnosis in, 261
- epidemiology of, 249
- etiology of, 248
- geographical distribution of, 247
- history of, 246
- lepra cells in, 253
- nerve, 257
- nodular, 255
- of rats, 252
- pathology of, 252
- prognosis in, 264
- prophylaxis in, 264
- symptomatology of, 254
- symptoms in detail of, 260
- synonyms for, 246
- transmission of, 251
- treatment of, 265
- Wasserman reaction in, 262
- Leptospira icteroides, 98
- icterohaemorrhagiae, 115
- morsus-muris, 118
- Leucocytosis, 534
- Leukopenia, 533
- Liver, alterations in size of, 558
- pains of, 559
- tropical, 166
- Liver abscess, 164, 501, 542, 550, 557, 558, 559
- Liver abscess, complications in, 166, 168
- diagnosis of, 169
- emetine in, 171
- etiology of, 164
- geographical distribution of, 164
- history of, 164
- operation for, 172
- pathology of, 165
- prophylaxis in, 171
- rupture of, 166
- symptomatology of, 166
- symptoms in detail of, 168
- treatment of, 171
- Liver fluke disease, 371
- Loa loa, 337, 352, 566
- Lunacy in the tropics, 610
- Lymphatic glands, in trypanosomiasis 76, 551
- system, 551
- Lymphocytosis, 536
- Lymph scrotum, 345
- Lyon blood tube, 516
- Maize in pellagra, 296
- Malaria, 1, 493, 494, 495, 496, 539, 548, 553, 560, 562, 566, 574, 579, 602, 605, 609
- algid, 34
- anaphylaxis and the paroxysm in, 18
- cachexia, 36
- cerebral, 33
- cultivation of parasite, 16
- definition of, 1
- diagnosis in, 40
- discovery of parasite, 2
- epidemiology of, 24
- etiology of, 4
- geographical distribution of, 4
- heredity in, 16
- history of, 1
- immunity in, 17
- in animals, 5
- index of, 9
- latent, 35, 493
- life history of parasite, 7
- [617]malignant tertian, 28, 30
- masked, 36
- mosquitoes in, 6, 18
- pathology of, 25
- perniciousness in, 31
- prognosis in, 42
- prophylaxis in, 42
- provocative measures in, 41
- quinine-affected parasites, 16, 17
- relapses in, 35
- sequelae of, 37
- symptomatology of, 27
- symptoms in detail of, 37
- synonyms for, 1
- toxin in, 7, 16
- transmission of, 7
- treatment of, 47
- variations in cycle, 27
- Malignant tumors, 488
- Malta fever, 237, 497, 541, 550, 554, 560, 579, 580, 593, 603, 604, 609
- clinical types of, 242
- complications in, 242
- definition of, 237
- diagnosis in, 243
- epidemiology of, 239
- etiology of, 238
- geographical distribution of, 238
- goat milk in, 239
- history of, 237
- pathology of, 240
- prognosis in, 244
- prophylaxis in, 245
- sequelae in, 242
- symptomatology of, 241
- symptoms in detail of, 242
- synonyms for, 237
- treatment of, 245
- Marris atropin test for fevers, 484
- Mastic test, 601
- Media, Aronson’s, 232
- Teague, 582
- Methylene blue, in malaria, 53
- Mexican typhus, 452
- Micrococcus melitensis, 238
- Monilia Candida, 474
- tropicalis, 474
- Mosquito, anatomy of, 20
- Anopheline, 18
- destruction, 43
- hibernation of, 21
- in dengue, 432
- in filariasis, 342
- in yellow fever, 105
- malaria transmitters, 6
- Moss’ blood grouping, 521
- Mouth, 586
- Mumps, 487
- Muscle involvement in tropical diseases, 592, 596
- Mycetoma, 399, 595
- diagnosis in, 402
- epidemiology of, 400
- etiology of, 400
- geographical distribution of, 399
- history of, 399
- pathology of, 401
- prognosis in, 403
- symptomatology of, 401
- treatment of, 403
- Mycoses, visceral, 473
- Myiasis, cutaneous, 421
- intestinal, 590
- larval characteristics, 590
- Myositis purulenta tropica, 597
- Nasal myiasis, 551, 568
- Nausea, 588
- Necator americanus, 320
- Neo-arsphenamine, administration of, 95
- Neurasthenia, 608
- Neurological manifestations, 598
- Night blindness, 567
- N. N. N. medium, 517
- Nocardia pseudotuberculosis, 474
- Nose, diseases of, 568
- Occult blood, 523, 571, 582
- Oedema, 555
- Oesophagus, 587
- Onchocerca volvulus, 339, 341, 354, 552
- Onyalai, 587
- [618]Opisthorchis felineus, 372
- Oriental sore, 137, 564
- diagnosis in, 139
- epidemiology of, 136
- etiology of, 123
- geographical distribution of, 136
- history of, 135
- pathology of, 137
- prophylaxis in, 140
- symptomatology of, 137
- synonyms for, 121
- treatment, 140
- Ornithodorus moubata, 89
- talaje, 91
- Oroya fever, 425, 541, 553, 595, 603
- etiology of, 426
- pathology of, 426
- prophylaxis in, 428
- symptomatology of, 427
- treatment of, 428
- Pappataci fever, 438, 545
- Paragonimiasis, 368, 549, 555
- diagnosis in, 371
- etiology of, 368
- history of, 368
- symptomatology of, 369
- Paragonimus westermanni, 368
- life history, 368
- Paralytic vertigo, 607
- Paratyphoid fever, 484, 503, 545
- Pediculi, 454
- Pellagra, 291, 492, 539, 561, 572, 586, 588, 589, 603, 605, 606, 608
- amino-acid deficiency in, 294
- animal experimentation in, 298
- blood in, 308
- corn in, 296
- definition of, 291
- diagnosis in, 308
- diagnostic triad in, 302
- epidemiology of, 298
- eruption of, 300, 303
- etiology of, 292
- experimental, 295
- geographical distribution of, 292
- history of, 291
- moulds and, 296
- Pellagra, mouth in, 586
- pathology of, 299
- periodic recurrences of, 302
- prognosis in, 309
- prophylaxis in, 309
- protein deficiency in, 294
- Simulium in, 298
- stages in, 302
- symptomatology of, 300
- symptoms in detail of, 308
- synonyms for, 291
- treatment of, 310
- urine in, 308, 572
- Penicillium crustaceum, 474
- Pernicious malaria, 31
- Phenolsulphonephthalein test, 577
- Phlebotomus fever, 438, 545
- pappatassii, 439
- Piedra, 420
- Pinta, 416
- Piroplasms, 58
- Plague, 188, 499, 542, 547, 549, 551, 559, 575, 602, 604, 605
- bubonic, 199
- confusing organisms in suspected, 191
- cutaneous, 200
- definition of, 188
- diagnosis in, 205
- epidemiology of, 192
- etiology of, 190
- Flugges droplet method, 197
- geographical distribution of, 189
- guinea pig test, 207
- Haffkine’s prophylactic, 211
- history of, 188
- pathology of, 198
- pneumonic, 197, 201, 549
- prognosis in, 208
- prophylaxis in, 208
- rat and, 191, 196
- septicaemic, 203
- symptomatology of, 199
- symptoms in detail of, 203
- synonyms for, 188
- tokens in, 200
- [619]treatment of, 211
- Yersin’s serum, 211
- Plasmodium falciparum, 12
- malariae, 11
- vivax, 10
- Pneumonia, 488
- Polyneuritis gallinarum, 275, 277
- Prickly heat, 561
- Proteosoma, 4
- Psychoses, 608
- Quinine, 45, 47
- administration of, 49
- in blackwater, 64
- idiosyncrasy to, 47
- prophylaxis, 45
- toxic effects, 47
- Rachialgia, 604
- Rand scurvy, 286
- Rat bite fever, 118, 502, 552, 563, 602
- definition of, 118
- epidemiology of, 118
- etiology of, 118
- pathology of, 119
- symptomatology of, 120
- treatment of, 120
- Rats and leprosy, 252
- and plague, 191, 196
- Reflexes, 606
- Relapsing fever, 86, 494, 495, 544, 550, 558, 560, 596, 604
- definition of, 86
- diagnosis in, 93
- epidemiology of, 89
- etiology of, 87
- geographical distribution of, 87
- history of, 86
- Panama and, 91
- pathology of, 91
- prognosis in, 94
- prophylaxis in, 94
- symptomatology of, 91
- symptoms in detail of, 92
- synonyms for, 86
- transmission of, 87
- by the louse, 88
- by the tick, 87
- treatment of, 94
- Remittent fever, 28
- Respiratory system, 548
- Rheumatic fever, 482
- Rhino-pharyngitis mutilans, 395
- Rhizomucor parasiticum, 474
- Rice and beriberi, 272
- Ringworm infections, 561
- Rocky Mountain spotted fever, 446, 502, 546, 558, 560, 563, 580, 602, 605
- definition of, 446
- diagnosis in, 449
- epidemiology of, 447
- etiology of, 447
- history of, 446
- pathology of, 448
- prophylaxis in, 449
- symptomatology of, 448
- synonyms for, 446
- treatment of, 450
- Romanowsky stains, 513
- Saline enemata, 65
- infusions in blackwater, 65
- in cholera, 235
- in heat stroke, 468
- Sand-fly fever, 441
- Sarcopsylla penetrans, 418
- Scarlet fever, 482
- Schilling-Torgau’s differential count, 514
- Schistosoma haematobium, 363
- japonicum, 364
- mansoni, 364
- Schistosomiasis, 357, 493, 546, 555, 560, 563, 575, 579, 589, 590, 606
- diagnosis in, 366
- etiology of, 357
- geographical distribution of, 363, 364
- history of, 360
- infection in, 357
- Japanese type, 364
- pathology of, 362
- prophylaxis in, 367
- rectal type, 364
- [620]symptomatology of, 363
- treatment of, 367
- urticarial fever in, 366
- vesical type, 363
- Schizogony, 7
- Schizotrypanum cruzi, 81
- Screw worm, 422, 568
- Scurvy, 286
- Seven-day fever, 440
- Ship beriberi, 285
- Simulium reptans, 292
- Six-day fever, 441
- Skin diseases, 561
- eruptions, 561
- Sleeping sickness, 66
- Smallpox, 486
- Somnolence, 603
- Spinal fluid, 598
- Spirillum cholerae asiaticae, 220
- Spironema duttoni, 87
- recurrentis, 86
- Spleen, enlargements of, 559
- pains of, 559
- puncture in kala-azar, 132, 559
- Sporogony, 8
- Sporotrichosis, 474
- Sporozoites, 8
- Spotted fever of the Rocky Mountains, 446
- Sprue, 312, 492, 538, 553, 559, 572, 586, 588, 589
- and hill diarrhoea, 316
- and pellagra, 316
- diagnosis in, 316
- etiology of, 313
- history of, 312
- pathology of, 314
- stools in, 316, 589
- symptomatology of, 314
- symptoms in detail of, 315
- tongue, 315, 586
- treatment of, 317
- Sputum examination, 548
- Statistics of cosmopolitan diseases, 481
- of intestinal parasites, 584
- Stegomyia calopus, 105, 433
- Stomach, 587
- Strongyloides stercoralis, 374
- Strongyloides stercoralis, life history of, 375
- symptoms of infestation, 374, 590
- treatment of infestation, 376
- Syphilis and liver abscess, 170
- and yaws, 392
- and tropical ulcer, 407
- in tropics, 488, 598
- Tabardillo, 451
- Table of arthropodan diseases, 382
- cosmopolitan diseases, 481
- filarial worms, 338
- helminthic diseases, 379
- intestinal bacteria, 177
- malarial parasites, 14
- protozoal diseases, 377
- Tartar emetic, 53, 80, 134, 140
- Temperature chart in blackwater fever, 498
- dengue, 495
- kala-azar, 498
- liver abscess, 501
- malaria, 493, 494, 495
- Malta fever, 497
- Oroya fever, 502
- plague, 499
- relapsing fever, 495
- trypanosomiasis, 500
- typhus fever, 500
- yellow fever, 498
- Tetanus, 488
- Thick film smears, 511
- Three-day fever, 441
- Thymol treatment, 332
- Ticks, 89, 447
- Tinea cruris, 414
- etiology of, 414
- symptomatology of, 414
- treatment of, 415
- Tinea imbricata, 411
- etiology of, 411
- symptomatology of, 412
- treatment of, 413
- Trachoma, 565
- Transfusion of blood, 521
- [621]Trematode diseases, 357, 368, 379
- Tremors, 605
- Trench fever, 460, 503, 596, 605
- definition of, 460
- diagnosis in, 462
- epidemiology of, 461
- etiology of, 461
- geographical distribution of, 461
- history of, 460
- pathology of, 462
- prognosis in, 463
- prophylaxis in, 463
- symptomatology of, 462
- synonyms for, 460
- treatment of, 463
- Treponema pertenue, 384
- Trichinosis, 534, 597
- Tropical liver, 166
- and syphilis, 170
- etiology of, 166
- symptomatology of, 166
- treatment of, 167
- ulcer, 407
- Trypanosoma brucei, 68, 84
- gambiense, 66, 68, 69
- nigeriense, 68
- rhodesiense, 67, 69
- Trypanosomes in animals, 84
- Trypanosomiasis, 66, 500, 543, 548, 551, 556, 563, 566, 603, 604, 605, 607, 608
- Brazilian, 80
- definition of, 66
- diagnosis in, 77
- epidemiology of, 70
- etiology of, 67
- geographical distribution of, 67
- history of, 66
- Kérandel’s sign in, 74
- pathology of, 72
- prognosis in, 78
- prophylaxis in, 78
- symptomatology of, 72
- symptoms in detail of, 76
- synonyms for, 66
- treatment of, 79
- Tsetse flies, 70
- Tsutsugamushi, 442
- diagnosis in, 445
- epidemiology of, 443
- etiology of, 443
- symptomatology of, 443
- Tuberculosis, 485
- Tularaemia, 213, 503, 552, 563
- definition of, 213
- diagnosis in, 217
- epidemiology of, 214
- etiology of, 214
- geographical distribution of, 213
- history of, 213
- pathology of, 215
- prognosis in, 217
- prophylaxis in, 217
- symptomatology of, 216
- synonyms for, 213
- treatment of, 217
- Tumbu fly disease, 423
- Typhoid fever, 483, 545
- Marris atropin test in, 484
- Typhus fever, 451, 500, 546, 548, 555, 558, 560, 565, 568, 587, 602
- definition of, 451
- diagnosis of, 457
- epidemiology of, 453
- etiology of, 452
- history of, 451
- louse in, 454
- pathology of, 454
- prophylaxis in, 458
- symptomatology of, 455
- synonyms of, 451
- treatment of, 459
- Urine, 570
- amount of, 573
- bacteriology of, 580
- bile pigment in, 572
- blood in, 571
- Erlich’s aldehyde test, 573
- Urobilinuria, 572
- in blackwater, 572
- Urticarial fever, 364, 493, 546, 563
- Uta, 138, 564
- [622]Varicella, 487
- Veld sore, 408
- Venereal diseases, 488
- Ver macaque, 421
- Verruga, 425, 428, 494
- pathology of, 428
- symptomatology of, 429
- treatment of, 430
- Viscerel mycoses, 474
- Vincent’s angina, 487
- Virus, filterable, in dengue, 432
- Vitamines, 271, 275, 288, 290, 293, 567
- Vomiting, 588
- sickness, 588
- Weil’s disease, 114, 544, 558, 559
- Wright’s staining method, 513
- Xerophthalmia, 567
- Yaws, 384, 494, 539, 553, 593
- and syphilis, 392
- diagnosis in, 391
- epidemiology of, 385
- etiology of, 384
- geographical distribution of, 384
- history of, 384
- inoculation experiments, 385
- pathology of, 386
- prognosis in, 393
- prophylaxis in, 393
- symptomatology of, 387
- Yaws, tertiary, 389
- treatment of, 393
- Yellow fever, 97, 498, 539, 547, 554, 557, 560, 566, 569, 573, 574, 575, 602, 604
- Bacillus icteroides, 101
- black vomit in, 109, 110
- Commission reports, 103
- definition of, 97
- diagnosis in, 111
- epidemiology of, 105
- etiology of, 98
- experimental work, 99, 103
- Faget’s law, 108
- geographical distribution of, 98
- history of, 97
- immune sera, use of, 113
- immunity in, 105
- Leptospira icteroides, 98
- pathology of, 107
- prognosis in, 112
- prophylaxis in, 112
- Stegomyia in, 101, 105
- symptomatology of, 108
- symptoms in detail of, 109
- synonyms for, 97
- treatment of, 112
- vaccination against, 112
- Yersin’s plague serum, 211
- Zygote, 9
TRANSCRIBER’S NOTE
Obvious typographical errors and punctuation errors have been corrected after careful comparison with other occurrences within the text and consultation of external sources.
Some hyphens in words have been silently removed, some added, when a predominant preference was found in the original book.
For consistency four occurrences of P2O5 (superscripts) have been changed to P2O5 (subscripts).
For consistency a few occurrences of the ligatures æ and œ have been replaced by ae and oe.
Except for those changes noted below, all misspellings in the text, and inconsistent or archaic usage, have been retained.
Pg xii: ‘CHAPTER LI ... 392.’ replaced by ‘CHAPTER LI ... 592.’.
Frontispiece: ‘MALARIAL PARASITIES’ replaced by ‘MALARIAL PARASITES’.
Pg 17: ‘become chilled’ replaced by ‘becomes chilled’.
Pg 21: ‘completely convered’ replaced by ‘completely covered’.
Pg 26: ‘matter fo fact’ replaced by ‘matter of fact’.
Pg 44: ‘part salcohol)’ replaced by ‘parts alcohol),’.
Pg 50: ‘must be sterlie’ replaced by ‘must be sterile’.
Pg 58: ‘apearances may not’ replaced by ‘appearances may not’.
Pg 100: ‘about the infecton’ replaced by ‘about the infection’.
Pg 102: ‘it would negative’ replaced by ‘it would negate’.
Pg 102: ‘could t have been’ replaced by ‘could not have been’.
Pg 122: ‘bodies, Lavaran’ replaced by ‘bodies, Laveran’.
Pg 128: ‘spleen, parcicularly’ replaced by ‘spleen, particularly’.
Pg 128: ‘pulp tords’ replaced by ‘pulp cords’.
Pg 128: For consistency the heading ‘Symptomatology’ has been changed
from bold to SmallCap at level h5.
Pg 133: ‘place in diaganosis’ replaced by ‘place in diagnosis’.
Pg 137: For consistency the heading ‘Symptomatology’ has been changed
from bold to SmallCap at level h5.
Pg 152: ‘magnesium oxdie’ replaced by ‘magnesium oxide’.
Pg 172: ‘dressing froceps’ replaced by ‘dressing forceps’.
Pg 177: ‘B. enteritidis’ replaced by ‘B. enteriditis’.
Pg 185: ‘than prophylatic’ replaced by ‘than prophylactic’.
Pg 187: ‘praise yaghurt’ replaced by ‘praise yoghurt’.
Pg 223: ‘district and among’ replaced by ‘districts and among’.
Pg 233: ‘The most scrupuous’ replaced by ‘The most scrupulous’.
Pg 235: ‘was striken by’ replaced by ‘was stricken by’.
Pg 249: ‘that of Kedrowski’ replaced by ‘that of Kedrowsky’.
Pg 256: ‘cernea and iris’ replaced by ‘cornea and iris’.
Pg 262: ‘nodular ases’ replaced by ‘nodular cases’.
Pg 262: ‘of mixed lepcosy’ replaced by ‘of mixed leprosy’.
Pg 265: ‘and very rarley’ replaced by ‘and very rarely’.
Pg 269: ‘of Berberi’ replaced by ‘of Beriberi’.
Pg 279: ‘formicaton of the’ replaced by ‘formication of the’.
Pg 291: ‘exacerabtions but’ replaced by ‘exacerbations but’.
Pg 309: ‘do not parallel’ replaced by ‘does not parallel’.
Pg 314: ‘mind. sprue patient’ replaced by ‘mind. The sprue patient’.
Pg 316: ‘Hill Diarrhea’ replaced by ‘Hill Diarrhoea’.
Pg 331: ‘phenolphthalin test’ replaced by ‘phenolphthalein test’.
Pg 332: ‘and chenopodiun’ replaced by ‘and chenopodium’.
Pg 334: ‘Carbon tetrachlorid’ replaced by ‘Carbon tetrachloride’.
Pg 350: ‘dose not involve’ replaced by ‘does not involve’.
Pg 381: ‘Broad Rusian’ replaced by ‘Broad Russian’.
Pg 393: ‘or with Giemas’ replaced by ‘or with Giemsa’.
Pg 436: ‘cases occuring in’ replaced by ‘cases occurring in’.
Pg 452: ‘eradicted from’ replaced by ‘eradicated from’.
Pg 466: For consistency the heading ‘Pathology’ has been changed
from italic to SmallCap at level h5.
Pg 469: ‘peculiarly o affect’ replaced by ‘peculiarly to affect’.
Pg 481: ‘Diarrhea and’ replaced by ‘Diarrhoea and’ (twice).
Pg 484: ‘a broncho-penumonia’ replaced by ‘a broncho-pneumonia’.
Pg 486: ‘is responsibile for’ replaced by ‘is responsible for’.
Pg 494: ‘with manifestaitons’ replaced by ‘with manifestations’.
Pg 501: ‘amoebic dystentery’ replaced by ‘amoebic dysentery’.
Pg 501: ‘that liver abcess’ replaced by ‘that liver abscess’.
Pg 507: ‘mixing throughly’ replaced by ‘mixing thoroughly’.
Pg 510: ‘Erhlich’s method’ replaced by ‘Ehrlich’s method’.
Pg 517: ‘ring of vsaeline’ replaced by ‘ring of vaseline’.
Pg 522: ‘pippette off the’ replaced by ‘pipette off the’.
Pg 527: ‘ension of alveolar’ replaced by ‘tension of alveolar’.
Pg 529: ‘are not synonomous’ replaced by ‘are not synonymous’.
Pg 530: ‘by bl d chemistry’ replaced by ‘by blood chemistry’.
Pg 532: ‘the ura ic, and’ replaced by ‘the uraemic, and’.
Pg 539: ‘febrile accesssions’ replaced by ‘febrile accessions’.
Pg 557: ‘liquor formaldehydi’ replaced by ‘liquor formaldehyde’.
Pg 573: ‘aldehyd reaction’ replaced by ‘aldehyde reaction’.
Pg 574: ‘adminstration of’ replaced by ‘administration of’.
Pg 590: ‘For more detailed’ replaced by ‘For a more detailed’.
Pg 596: ‘and multilation are’ replaced by ‘and mutilation are’.
Pg 598: ‘howevert, unless’ replaced by ‘however, unless’.
Pg 605: ‘endo- and perineurium’ replaced by ‘endoneurium and perineurium’.